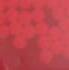

KOSTENLOSE BESTELLHOTLINE TEL 0800–567 21 21 FAX 0800–567 21 24 service@oppermann.de www.oppermann.de Nur für den gewerblichen Bedarf. Alle Preise zzgl. MwSt. HERBST 2022 TRINKGEFÄSSEBAMBOO ab 5 95 Seite 7





















































RUNDUMSERVICE INDIVIDUELLEDRUCKBERATUNGWERBESCHNELLE LIEFERUNG DURCH DRUCKEREIHAUSEIGENEUNDLAGER GRAFIKSERVICE WERBEARTIKELBRANCHESEITKORREKTURABZUGKOSTENLOSERÜBER80JAHRENERFAHRUNGINDER NEWSLETTER ABONNIEREN UND VORTEILE SICHERN KOSTENLOSE BESTELLHOTLINE Tel 0800–567 21 21* Fax 0800–567 21 24* Mail service@oppermann.de Web www.oppermann.de * Mo bis Fr 7.30 – 17.30 Uhr Kauf auf Rechnung UNSER GESAMTES SORTIMENT FINDEN SIE AUF oppermann.de 6 –37 || NEUHEITEN 338 Innovative & neue Werbemittel 38 – 89 || NACHHALTIG Umweltfreundliche Produkte 90 – 101 || WERBESETS Werbepakete für einen Preis 102 – 124 || SCHREIBER Die bunte Welt der Schreibartikel 125 – 191 || WERBEIDEEN Marktplatz kreativer Vielfalt 192 – 225 || FREIZEIT Textiles für Outdoor und Indoor 226 – 270 || KALENDER Wand-, Buch- und Bildkalender 271 – 282 || SPIELWAREN Für kleine und große Kunden 283 – 289 || SÜSSWAREN Naschen und Knabbern geht immer 290 – 307 || WEIHNACHTEN Dekoration, Adventskalender uvm. 308 – 313 || GESCHENKE Marken und hochwertige Geschenke 314 – 321 || TECHNIK Rund um die digitale Welt 322 – 328 || GESUNDHEIT Hygiene- und Gesundheitsartikel 329 – 334 || SALES Schnäppchenjäger aufgepasst 335 – 337 || SERVICE Informationen
Florian GeschäftsführerNeidig SURVIVAL PRODUKTSORTIMENT!UNSEREM Kurt GeschäftsführerSchnellbächer
Auf Seite 36/37 finden Sie farbenfroh bedruckte Werbetextilien. Bereits ab kleinen Mengen zu einem Top-Preis.
Bleiben Sie gesund und zuversichtlich! Wir sind für Sie da.
LASSEN SIE SICH VON UNSEREM NEUEN PRODUKTSORTIMENT INSPIRIEREN – SO VIELFÄLTIG UND BUNT WIE DER HERBST Bunte Blätter, luftige Winde – nach einem heißen Sommer freuen wir uns über angenehme Temperaturen und den Herbst in seiner ganzen Farbenpracht. Über lange Jahre etablierte und sichere Lieferketten ermöglichen uns, Ihnen trotz weltweiter Rohstoffknappheit und steigender Energiepreise unser gesamtes vielfältiges und umfangreiches Sortiment anbieten zu können. Schnell und zuverlässig wie gewohnt! Denn Dank eigener Druckerei können wir auch auf kurzfristige Anfragen unmittelbar reagieren. Entdecken Sie in diesem Katalog wieder jede Menge spannende NEUHEITEN! Den schnell wachsenden Bereich SURVIVAL haben wir um tolle neue Produkte erweitert. Und auch die Auswahl NACHHALTIGER Produkte wächst ständig. Neu sind zum Beispiel Artikel aus recyceltem Leder. Unser Tipp: Denken Sie jetzt schon an WEIHNACHTEN, dann können Sie dem Jahresendspurt umso gelassener entgegenschauen und das Spätsommerfeeling genießen. Neben vielfältigen GESCHENKIDEEN finden Sie bei uns eine große Auswahl an KALENDERN für das Jahr 2023 und damit eines der nachhaltigsten Werbegeschenke. Ob Tisch-, Taschen oder großformatiger Wandkalender mit spektakulären Fotomotiven – aktuell steht Ihnen noch die gesamte Auswahl zur Verfügung.
Ihr OPPERMANN-Serviceteam PS: Abonnieren Sie unseren NEWSLETTER und profi tieren Sie von unseren vielen VIP-Vorteilen!
NEU IN

















einen Überblick über die inneren Werte unserer nachhaltigen FARE ERHÄLT 2022!CAMPAIGN”„SUSTAINABLEDENAWARD FARE hat das waterSAVE® Bezugsmaterial für seine Schirme eingeführt, das aus recycelten Kunststoffen hergestellt wird. In der prämierten Händler-Kampagne zur Absatzsteigerung der waterSAVE® Schirmmodelle spendet Fare pro eingespartem Liter Wasser bei der Schirmproduktion Geld an die Organisation „Viva con Agua“. Nachhaltige Produktion, ein klar formuliertes Umweltziel in Verbindung mit einem klaren Kampagnenziel haben die Jury überzeugt.
FREUNDLICHPRODUKTEWIRTOP-SELLERNACHHALTIGENUNSEREVEREDELNIHREUMWELTUnsere Siebdruckfarben auf Wasserbasis enthalten keinerlei Giftstoffe, was sie sehr umweltfreundlich macht. Auch bei der Reinigung der Druckmaschinen setzen wir auf umweltschonende Verfahren: Anstelle von flüchtigen, EindruckdurchSoNano-Reinigungs-Technologie.ReinigernlösungsmittelhaltigennutzenwirinnovativekönnenauchSieeinenunddurchnachhaltigenhinterlassen.
Auch wir stellen uns unserer Verantwortung. Schritt für Schritt optimieren wir die Prozesse in allen Bereichen. So haben wir Anfang 2022 von Ökostrom auf reinen Naturstrom umgestellt.
Das Thema Nachhaltigkeit beschäftigt uns längst nicht nur bei der Auswahl neuer Werbeartikel.
Außerdem investiert NATURSTROM für jede von uns verbrauchte Kilowattstunde einen garantierten Betrag in den Bau neuer Öko-Kraftwerke. Und das mit großem Erfolg: Schon mehr als 300 Solar-, Wasser- und Windkraft-anlagen sind auf diese Weise in Deutschland entstanden.
Werbemitteln und Streuartikeln. Ökologische Produkte aus nachwachsenden und recycelten Materialien. Aus Bambus, Weizenstroh oder Zuckerrohr, aus recyceltem Papier, Glas oder PET. Sie finden bei uns jede Menge neue Trends und Ideen, die keineswegs teurer sein müssen und vor allem mit ihren tollen Designs Materialzusammensetzungbegeistern. eines Produktes ist nicht immer von außen erkennbar. Mit unseren Symbolen bieten wir Ihnen Produkte. Dabei erfahren Sie längst nicht nur, welche Rohstoffe verwendet werden, sondern erhalten auch bestmögliche Einsicht in Herstellungsprozesse, Handelsbedingungen und Zertifizierungen oder ob es sich um in Deutschland produzierte Artikel zur Vermeidung von Transportwegen handelt. Diese Transparenz ist uns wichtig und bietet Ihnen die Möglichkeit für Werbe- und Imageerfolge mit bestem Gewissen.
Dieser wird CO2-neutral ausschließlich aus erneuerbaren Energien, vor allem Wasser- und Windkraft, erzeugt. Was uns dabei besonders überzeugt: Bei NATURSTROM werden sämtliche CO2-Emmissionen, die zum Beispiel beim Bau von ÖkoEnergieanlagen entstehen, über Klimaschutzprojekte nach Gold Standard (VER) neutralisiert.
WIR NUTZEN 100 % NATURSTROM
UMWELT













Eine Legende aller Symbole finden Sie in unserem Service-Bereich auf Seite 287
BIENEN & BLUMEN Blumen- und bienenfreundliche Produkte sind wichtig, um das Gleichgewicht unserer Umwelt wieder herzustellen. Ein kleiner Beitrag, den jeder leisten kann.
UP UPCYCLING Ganz nach dem Motto „Aus Alt mach Neu“ entstehen durch Upcycling aus scheinbar nutzlosen Abfallprodukten ganz neue, oftmals überraschende und wertvolle Dinge. Diese Nachnutzung von Rohstoffen schont unsere natürlichen Ressourcen erheblich.
WEIZENSTROH Tatsächlich handelt es sich bei dem genutzten Rohstoff um ein Abfallprodukt aus der Landwirtschaft, welcher zur Reduktion von Kunststoff eingesetzt werden kann. Produkte aus Weizenstroh sind frei von den üblichen Weichmachern und Konservierungsstoffen.
LEDER Leder ist ein hochwertiger Naturstoff. Es ist überaus strapazierfähig und alterungssowie temperaturbeständig. Da es sich um ein Naturprodukt handelt, dass sich mit der Zeit verändert, ist eine regelmäßige Pflege sehr wichtig. So bleiben die tollen Eigenschaften für eine lange Freude am Produkt erhalten.
ZUCKERROHR
HOLZ Holz aus nachhaltiger Waldwirtschaft ist äußerst umweltfreundlich, da Bäume CO2 absorbieren und Sauerstoff produzieren. Auch nach einem langen Lebenszyklus wirken sich Holzprodukte günstig auf die Umwelt aus: Holz lässt sich problemlos wiederverwerten oder umweltfreundlich entsorgen.
RECYCELTES PAPIER Recyclingpapier wird durch die Wiederverwertung von Altpapier, Pappe sowie Karton gewonnen. Es muss kein Holz geschlagen werden. Für die Herstellung wird weniger als die Hälfte an Energie und bis zu 70 Prozent weniger Wasser als für Frischfaserpapier benötigt.
KORK Kork ist sehr nachhaltig, da er vom Baum stammt, dieser aber nicht gefällt werden muss. Nur die nachwachsende Rinde der Korkeiche wird geerntet. Kork ist daher ein effizienter, erneuerbarer Rohstoff, der auch keinen Abfall erzeugt. Dies liegt daran, dass Kork sowohl recycelbar als auch biologisch abbaubar ist.
WIR BEGLEITEN SIE DURCH DEN KATALOG UMWELTFREUNDLICHE UND NACHHALTIGE PRODUKTE AUF EINEN BLICK ERKENNEN
BAUMWOLLE Baumwolle ist per se ein nachwachsender Rohstoff und – essenziell wichtig - biologisch abbaubar. Die gesamte Baumwollpflanze wird für die Ernte verwendet. Der wirtschaftliche Aspekt gehört ebenfalls zur Nachhaltigkeit: Im Baumwollanbau verdienen grob geschätzt rund 200 Millionen Menschen ihren Lebensunterhalt.
ORGANIC ORGANIC PLASTIC Wenn es um wertige Produkte mit hoher Langlebigkeit geht, können bio-basierte Kunststoffe eine tolle Alternative sein. Diese werden auf Basis von nachwachsenden Rohstoffen wie Mais, Zuckerrohr, Zuckerrüben, Raps oder Palmöl erzeugt und unterscheiden sich in ihren Eigenschaften nicht von konventionellen Kunststoffen.
TEP RPET / PET Recycelter Kunststoff und RPET sparen den Einsatz fossiler Brennstoffe in der Produktion. Außerdem wird bei der Herstellung von RPET weniger CO2 ausgestoßen und weniger Wasser als bei Kunststoff verwendet. Wie wäre es wenn all die Millionen von PET-Flaschen ab jetzt ein zweites Leben bekämen, anstatt den Plastikberg immer größer werden zu lassen?
BAMBUS Bambus boomt und ist als Ersatz für Plastik absolut sinnvoll. Bambus ist ein schnell nachwachsender Rohstoff, der sehr widerstandsfähig gegenüber Umwelteinflüssen ist. Ein weiterer Pluspunkt: Bambuspflanzen binden bis zu viermal mehr CO2 als andere Baumarten.
Eine nachhaltige und umweltfreundliche Alternative für die Plastik- und Papierproduktion, bei der viel weniger Energie aufgewendet wird. Produkte aus Zuckerrohr sind nach Gebrauch biologisch abbaubar, zersetzen sich schnell.











































































280 ml 500 ml 750 ml 700 ml1000 ml Lieferung nur für den gewerblichen Bedarf. Alle Preise zzgl. MwSt.6 | NEUHEITEN 3 GLAS-FRISCHHALTEBOX 750ml Frischhaltebox aus Glas mit verschließbarem Deckel, 750 ml Fassungsvermögen und Silikon Dichtung. Für Mikrowelle und Gefrierschrank geeignet, lebensmittelecht und leicht verstaubar. Maße: 15, 7 x 15,7 x 6,5 cm W Werbedruck. Fläche: auf Deckel 70 x 70 mm Preis/Stk.: ab 15 Stück 2,35 226 499 ab 4,95 2 VORRATSDOSE AUS BOROSILIKATGLAS Vorratsdose aus Borosilikatglas mit Holzdeckel und Silikonring. Borosilikatgläser weisen folgende Eigenschaften auf: sie sind extrem hitzebeständig, leicht und doch stabil, chemikalienfrei, geschmacksund geruchsneutral und eine umweltfreundlichere Alternative, da Borosilikatglas nach dem Einschmelzen vollständig recyclebar und wiederverwendbar ist! Maße: 700 ml: 10,2 x 14,2 cm; 1000 ml: 10,2 x 17,2 cm W Werbedruck. Fläche: auf Deckel 60 x 60 mm Preis/Stk.: ab 20 Stück 1,75 L Lasergravur. Fläche: auf Deckel 60 x 60 mm Preis/Stk.: ab 20 Stück 2,25 Werkzeugkosten: Siehe Serviceseiten. 226 474 700 ml ab 3,95 226 482 1000 ml ab 4,15 1 VORRATSGLAS „CLICKY“ Vorratsglas mit Bügelverschluss und weißem Silikonring: zum Einmachen, Einkochen oder Aufbewahrung von Lebensmitteln, vormontierter Deckel, einfaches Öffnen und Schließen, vielseitig verwendbar. 226 101 S (280 ml) 2,49 226 110 M (500 ml) 2,99 226 128 L (750 ml) 3,49 4 BESTECKSET OUTDOOR CAMPING 3-teiliges Outdoor-Besteck-Set bestehend aus einem zusammenklappbarem Messer, einer Gabel und einem Löffel. Mit Dosen-/ Flaschenöffner Funktion. In Nylonbeutel mit Klettverschluss und Trageschlaufe. Maße: 16,2 x 1,5 cm SP Spezialsiebdruck. Fläche: auf das Etui 50 x 40 mm Preis/Stk.: ab 20 Stück 2,25 Werkzeugkosten: Siehe Serviceseiten. 226 273 ab 3,95 STÜCKAB STÜCK-PREIS 1.DRUCKFARBE 1 6,25 20 5,95 2,25 50 5,45 1,95 100 4,95 1,65 250 4,45 1,25 500 3,95 -,95 Druckkosten weitere Farben: siehe Onlineshop 4 OUTDOORBESTECKSETCAMPING ab 3 95 STÜCKAB STK.-PREIS700ml STK.-PREIS1000ml 1.DRUCKFARBE GRAVURLASER5002501002016,256,55–5,956,251,752,25505,455,751,501,954,955,251,251,754,454,75-,951,253,954,15-,75-,95DruckkostenweitereFarben:sieheOnlineshop STÜCKAB STÜCK-PREIS 1.DRUCKFARBE 1 8,45 15 7,95 2,35 30 7,45 1,95 100 6,95 1,75 250 5,95 1,25 500 4,95 -,95 Druckkosten weitere Farben: siehe Onlineshop 1 „CLICKY“VORRATSGLAS ab 2 49 2 VORRATSDOSE BOROSILIKATGLASAUS ab 3 95 3 750MLFRISCHHALTEBOXGLASab 4 95 zusammenklappbar Holzdeckel mit Silikonverschluss






















































































































































































STÜCKAB STÜCK-PREIS 1.DRUCKFARBE 1 11,95 12 10,95 3,25 30 9,95 2,55 100 8,95 1,95 250 7,95 1,55 500 6,95 1,25 Druckkosten weitere Farben: siehe Onlineshop STÜCKAB STÜCK-PREIS 1.DRUCKFARBE 1 10,95 12 9,95 3,25 30 8,95 2,55 100 7,95 1,95 250 6,95 1,55 500 5,95 1,25 Druckkosten weitere Farben: siehe Onlineshop STÜCKAB STÜCK-PREIS 1.DRUCKFARBE 1 12,95 10 11,95 3,35 30 10,95 2,55 100 9,95 1,95 200 8,95 1,55 300 7,95 1,25 Druckkosten weitere Farben: siehe Onlineshop 2 350„BAMBOOISOLIERBECHERGO“ML ab 6 95 3 450„BAMBOOISOLIERBECHERDRINK“ML ab 5 95 1 450„BAMBOOISOLIERBECHERSPACE“ML ab 7 95 Teesiebmit Schnellverschlussmit
BAMBUSTOGO 7NEUHEITEN |
3 ISOLIERBECHER „BAMBOO DRINK“ 450 ml Bambus trifft Edelstahl: ein Glücksfall für warme Getränke! Deckel mit Silikondichtung und integrierter Trinköffnung sowie beschichteten Boden für gute Oberflächenhaftung. Doppelwandig. Maße: Ø 8,2 x 17,5 cm W Werbedruck. Fläche: Vorderseite 20 x 80 mm Preis/Stk.: ab 12 Stück 3,25 Werkzeugkosten: Siehe Serviceseiten. 226 257 ab 5,95 1 ISOLIERBECHER „BAMBOO SPACE“ 450 ml Elegante doppelwandige Isolierkanne in der tollen Kombination Bambus-Ummantelung und Edelstahl. Der Deckel kann als Becher verwendet werden. Deckel-Innenwand und Ausgießer sind aus stoßfestem Kunststoff. Maße: Ø 6,8 x 23,8 cm W Werbedruck. Fläche: Vorderseite 20 x 80 mm Preis/Stk.: ab 10 Stück 3,35 Werkzeugkosten: Siehe Serviceseiten. 226 265 ab 7,95
2 ISOLIERBECHER „BAMBOO GO“ 350 ml Dieser doppelwandige Edelstahl-Isolierbecher begeistert mit seiner edlen Bambus-Ummantelung alle. Der Deckel ist mit einem sicheren Schraubverschluss und einer Silikondichtung ausgestattet. Ein herausnehmbares Teesieb wird mitgeliefert. Maße: Ø 6,5 x 19,8 cm W Werbedruck. Fläche: Vorderseite 20 x 80 mm Preis/Stk.: ab 12 Stück 3,25 Werkzeugkosten: Siehe Serviceseiten. 226 249 ab 6,95





















































































































BESTÄNDIGE WERBEARTIKEL SINNVOLLE HINGUCKER
Lieferung nur für den gewerblichen Bedarf. Alle Preise zzgl. MwSt.8 | NEUHEITEN
STÜCKAB STÜCK-PREIS 1.DRUCKFARBE GRAVURLASER-
ab 25 Stück 1,80 Werkzeugkosten: Siehe Serviceseiten. 226 706 ab 2,99 2 FLASCHENÖFFNERBAMBUSab 0 99 3 BAMBUS-TASCHENMESSER ab 2 99 STÜCKAB STÜCK-PREIS 1.DRUCKFARBE GRAVURLASERDruckkosten1.000500250100502515,95–5,451,401,805,251,201,604,951,-1,404,45-,901,203,95-,801,103,29-,70-,95weitereFarben:sieheOnlineshop STÜCKAB STÜCK-PREIS 1.DRUCKFARBE GRAVURLASER-
3 BAMBUS-TASCHENMESSER Dieses Taschenmesser aus Edelstahl mit Bambusgriffzone, Sicherheitsverschluss und eine Aufhängeschlaufe kann sich sehen lassen. Nachhaltig und praktisch. Maße: 9,9 x 1,2 x 2,2 cm W Werbedruck. Fläche: auf eine Seite 40 x 5 mm Preis/Stk.: ab 25 Stück 1,40 L Lasergravur. Fläche: auf eine Seite 40 x 5 mm Preis/Stk.:
Druckkosten1.500500250100502515,35–4,951,401,804,751,201,604,451,-1,403,95-,901,203,45-,801,102,99-,70-,95weitereFarben:sieheOnlineshop
Druckkosten5.0002.5001.0003001507011,95–1,85-,50-,801,75-,45-,701,55-,40-,601,35-,35-,551,15-,30-,50-,99-,25-,45weitereFarben:sieheOnlineshop
ab 3
Der Bambusdeckel der Keramiktasse hat eine passende Aussparung für den farblich abstimmten Keramiklöffel. Füllvermögen: 300ml Maße: 8,5 x 10,2 cm W Werbedruck. Fläche: auf Deckel 50 x 40 mm Preis/Stk.: ab 25 Stück 1,40 L Lasergravur. Fläche: auf Deckel 50 x 40 mm Preis/Stk.: ab 25 Stück 1,80 Werkzeugkosten: Siehe Serviceseiten. 226 595 weiß ab 3,29 226 587 schwarz ab 3,29
1 KERAMIKTASSE &/-LÖFFEL MIT BAMBUSDECKEL 29 2 BAMBUS-FLASCHENÖFFNER Auf diesen handlichen Flaschenöffner aus Metall mit Bambusummantelung ist überall dort Verlass, wo man ihn braucht. Maße: 3,9 x 1 x 6,8 cm W Werbedruck. Fläche: auf eine Seite 30 x 20 mm Preis/Stk.: ab 70 Stück -,50 L Lasergravur. Fläche: auf eine Seite 30 x 20 mm Preis/Stk.: ab 70 Stück -,80 Werkzeugkosten: Siehe Serviceseiten. 226 691 ab -,99
1 KERAMIKTASSE &/-LÖFFEL MIT BAMBUSDECKEL

























































































MITEDELSTAHL-TRINKBECHERHENKEL
DOPPELWANDIGEDELSTAHL-TRINKFLASCHE
Druckkosten1.000500250100301518,95–8,552,403,257,952,202,957,451,602,256,951,251,756,45-,951,255,95-,801,10weitereFarben:sieheOnlineshop GRAVURLASER-
3
ab 5,95 226 626 schwarz ab 5,95 226 618 kupfer ab 5,95 1 MITTRINKBECHEREDELSTAHL-HENKEL ab 5 75 2 DOPPELWANDIGTRINKFLASCHEEDELSTAHLab 5 95 3 DOPPELWANDIGTRINKBECHEREDELSTAHLab 5 95 STÜCKAB STÜCK-PREIS 1.DRUCKFARBE GRAVURLASERDruckkosten500250100301518,45–8,252,403,257,752,202,956,751,602,256,251,251,755,75-,951,25weitereFarben:sieheOnlineshop STÜCKAB STÜCK-PREIS 1.DRUCKFARBE GRAVURLASER-
2
DOPPELWANDIGEDELSTAHL-TRINKBECHER
STÜCKAB STÜCK-PREIS 1.DRUCKFARBE
Druckkosten50025010050251218,95–8,452,953,957,952,503,507,451,952,756,951,652,256,451,251,755,95-,951,25weitereFarben:sieheOnlineshop
9NEUHEITEN | 1
Doppelwandiger Edelstahltrinkbecher mit Henkel. Der transparente Deckel verfügt über eine Trinkschiebeleiste. Füllvermögen: 300 ml Maße: 8,8 x 8,5 cm W Werbedruck. Fläche: seitlich 35 x 35 mm Preis/Stk.: ab 15 Stück 2,40 L Lasergravur. Fläche: seitlich 50 x 40 mm Preis/Stk.: ab 15 Stück 3,25 Werkzeugkosten: Siehe Serviceseiten. 226 667 weiß ab 5,75 226 659 schwarz ab 5,75 226 642 bronze ab 5,75
Doppelwandiger Vakuum-Trinkbecher aus Edelstahl. Der transparente Trinkverschlussdeckel ist ergonomisch geformt für ein angenehmes Trinkgefühl. Füllvermögen: 380 ml Maße: 8 x 11,2 cm W Werbedruck. Fläche: seitlich 30 x 30 mm Preis/Stk.: ab 12 Stück 2,95 L Lasergravur. Fläche: seitlich 60 x 30 mm Preis/Stk.: ab 12 Stück 3,95 Werkzeugkosten: Siehe Serviceseiten. 226 634 weiß
Diese elegante doppelwandige Vakuumflasche aus Edelstahl besticht mit ihrer gebürsteten Oberfläche und schmalem Hals. Mit auslaufsicherem Verschluss aus Kunststoff und Edelstahl. Füllvermögen: 500 ml Maße: 7 x 24,7 cm W Werbedruck. Fläche: seitlich 20 x 70 mm Preis/Stk.: ab 15 Stück 2,40 L Lasergravur. Fläche: seitlich 30 x 80 mm Preis/Stk.: ab 15 Stück 3,25 Werkzeugkosten: Siehe Serviceseiten. 226 683 schwarz ab 5,95 226 675 bronze ab 5,95
TrinkschiebeleisteMit













































































































































Lieferung nur für den gewerblichen Bedarf. Alle Preise zzgl. MwSt.10 | NEUHEITEN 1 SCHWARZKRAFTSTOFFKANISTER Diese Kraftstoffkanister aus bruchsicherem Polyethylen (HD-PE) mit UN-Zulassung für Benzin (E10 geeignet), Diesel und andere Gefahrgüter erfüllen höchste Sicherheitsanforderungen. Inkl. Auslaufrohr und unverlierbarer Kindersicherheitsverschraubung. Hinweis: Zur Kennzeichnung (gemäß GHS-Verordnung sowie ADR) von mit Kraftstoff gefüllten Kanistern müssen Sie verwenden.Gefahrkennzeichnungs-Etiketten Maße: 5 l: 14,7 x 26,5 x 24,7 cm; 10 l: 16,4 x 33,3 x 32,4 cm; 20 l: 17,8 x 36,5 x 43,5 cm. 226 281 5 l 4,95 226 290 10 l 8,95 226 304 20 l 13,95 Gleich mitbestellen: ETIKETTEN ZUR KENNZEICHNUNG VON KRAFTSTOFFKANISTERN 226 345 2,50 2 WASSERKANISTER WEISS Wasserkanister mit Auslaufrohr, weiß aus bruchsicherem Polyethylen (HD-PE). Unverlierbare Verschraubung, platzsparend stapelbar. Die gute chemische Beständigkeit gegen Fette, Harze, Laugen, Öle und Säuren macht diesen Kanister lebensmittelgeeignet. Temperaturbeständig von -20°C bis +70°C. Bisphenol A (BPA) frei. Maße: 12 l: 16 x 29 x 33,1 cm; 22 l: 19 x 37 x 44 cm 226 312 12 l 12,95 226 329 22 l 17,95 1 SCHWARZKANISTERKRAFTSTOFFab 4 95 2 WEISSWASSERKANISTER ab 12 95 Mit Auslaufrohr Mit Ausschenkhahn Etiketten zur Kennzeichnung von Kraftstoffkanistern 5 l 10 l 20 l 22 l 12 l MADE GERMANYIN KANISTER EINSETZBARVIELSEITIG MADE GERMANYIN





























































































ab 2
1 MITINRPET-HANDTUCHRPET-BEUTELKORDELZUGVERSCHLUSS 1 95
226
3 FALTBARER SPATEN „SCOOP“ MIT TASCHE Faltbarer Spaten aus Karbonstahl mit Tasche: Multifunktionsschaufel mit Dreiecksgriff, kompakt, leicht und tragbar, Schaufelbrett mit integrierter Säge Maße: 11,5 x 46 bzw. 16 x 21 x 5 cm SP Spezialsiebdruck. Fläche: auf Etui 90 x 80 mm Preis/Stk.: ab 15 Stück 2,95 Werkzeugkosten: Siehe Serviceseiten. 136
Multi-Fahrradwerkzeug aus Metall und Holz. Das kleine handliche Tool sollte auf der nächsten Radtour nicht fehlen. 2 Schraubendreher, 6 Hexaschlüssel und Multi- Schraubmutterschlüssel Maße: 9,5 x 3,3 x 1,7 cm W Werbedruck. Fläche: auf Schale 50 x 10 mm Preis/Stk.: ab 25 Stück 1,40 L Lasergravur. Fläche: auf Schale 50 x 10 mm Preis/Stk.: ab 25 Stück 1,80 Werkzeugkosten: Siehe Serviceseiten. 226 600 ab 2,95 MITFAHRRADWERKZEUGHOLZVERSCHALUNG 95
ab 5,95 3 FALTBARER SPATEN MIT„SCOOP“TASCHE ab 5 95 STÜCKAB STÜCK-PREIS 1.DRUCKFARBE 1 8,95 15 7,95 2,95 30 7,45 2,25 100 6,95 1,75 250 6,45 1,35 500 5,95 -,95 Druckkosten weitere Farben: siehe Onlineshop STÜCKAB STÜCK-PREIS 1.DRUCKFARBE GRAVURLASERDruckkosten1.000500250100502515,25–4,951,401,804,751,201,604,451,-1,403,95-,901,203,45-,801,102,95-,70-,95weitereFarben:sieheOnlineshop 1 MITINRPET-HANDTUCHRPET-BEUTELKORDELZUGVERSCHLUSS Wussten Sie, dass recyceltes PET sich hervorragend als Garnstoff eignet? Diese Handtücher liefern den saugkräftigen Beweis dafür. In 3 Farben, im praktischen Beutel erhältlich. Maße: 79 x 30 cm SP Spezialsiebdruck. Fläche: auf Tasche 80 x 80 mm Preis/Stk.: ab 40 Stück 1,20 Werkzeugkosten: Siehe Serviceseiten. 226 520 grau ab 1,95 226 538 rot ab 1,95 226 546 blau ab 1,95 STÜCKAB STÜCK-PREIS 1.DRUCKFARBE 1 3,35 40 3,15 1,20 100 2,95 1,10 250 2,75 -,90 500 2,45 -,80 1.000 2,25 -,70 2.500 1,95 -,60 Druckkosten weitere Farben: siehe Onlineshop 79 x 30 cm
TEP 11NEUHEITEN | Zusammenfaltbarinkl.Etui 2
2
MITFAHRRADWERKZEUGHOLZVERSCHALUNG




















































































12
2 ESBIT KAFFEEKOCHEREDELSTAHL Klein, leicht und damit einfach praktisch: dieser einzigartige Edelstahl Kaffeekocher verspricht ungetrübten Kaffeegenuss. Der Kaffeefilter ist besonders feinmaschig. Zu befeuern mit 2 x 5 g Trockenbrennstoff-Tabletten. Für ca. 200 ml Kaffee oder heißes Wasser, mit praktischem Netzbeutel. Maße: 10,8 x 11 cm Hinweis: Nicht für den Wiederverkauf freigegeben. 226 048 49,95 Gleich mitbestellen: ESBIT TABLETTENTROCKENBRENNSTOFF16 Stk. à 5 g 226 056 =
WARTET! Lieferung nur
ESBIT KOCHSETTROCKENBRENNSTOFF1000 ml Mit dem 1000 ml TrockenbrennstoffKochset aus extrem leichtem, hartanodisiertem Aluminium macht Reisen Spaß, denn es beschwert das Gepäck mit einem Gewicht von nur etwa 314 g kaum. Anfeuern lässt sich das Kochset mit zwei 14 g Esbit TrockenbrennstoffTabletten. Der Deckel kann während des Kochens praktisch am Rand des Topfes aufgehängt werden. Der Stand lässt sich im Inneren des Topfes für den Transport verstauen, sodass das Kochset ein besonders kleines Packmaß hat. Maße: 15,7 x 8,8 cm Hinweis: Nicht für den Wiederverkauf freigegeben. 226 021 59,95 Gleich mitbestellen: ESBIT TABLETTENTROCKENBRENNSTOFF12 Stk. à 14 g 226 030 9,95
Alle Preise zzgl.
1
OUTDOOR-LIEBE DAS ABENTEUER für den gewerblichen Bedarf. MwSt.|
NEUHEITEN
4,95 1 ESBIT 1000KOCHSETTROCKENBRENNSTOFF-ML 59 95 2 ESBIT KAFFEEKOCHEREDELSTAHL 49 95 superkleinundleicht klappbare Griffe
kleines Packmaß































2 ESBIT SPIRITUS-KOCHSET
13NEUHEITEN |
Der große Taschenkocher aus elektrolytisch verzinktem Stahl ist immer noch klein genug, um ihn problemlos auf jede Tour mitzunehmen. 12 Trockenbrennstoff-Tabletten à 14 g mit einer Brenndauer von je ca. 12 Minuten gehören zum Lieferumfang. Der Brennstoff lässt sich bequem direkt im Kocher transportieren. Die Kocherposition ist in 3 Stufen wählbar. Maße: 13,2 x 9,6 x 3,9 cm 226 064 19,95 Gleich mitbestellen: ESBIT TABLETTENTROCKENBRENNSTOFF12 Stk. à 14 g 226 030 9,95
1500 ml Großes Volumen – geringes Gewicht: Mit nur etwa 466 g und einem Fassungsvermögen von bis zu 1500 ml ist dieses Spiritus-Kochset aus hartanodisiertem Aluminium besonders für längere Touren ein angenehmer Begleiter. Der Deckel des Kochsets lässt sich während des Kochens einfach am Topfrand aufhängen. Das Set lässt sich platzsparend, Stand im Topf verstaut, in einem Netzbeutel transportieren. Zum komfortablen Löschen der Flamme verfügt der Flammenregulierer des Brenners über einen Klappgriff. Maße: ca. 15,4 x 15,4 x 11,5 cm Hinweis: Nicht für den Wiederverkauf freigegeben.
226 089 79,95
1 ESBIT TASCHENKOCHER
Dieses universell einsetzbare, robuste Besteck-Set aus Titan spart an der richtigen Stelle: beim Gewicht. Es ist extrem leicht und durch sein außergewöhnliches Design auch ein optischer Blickfang. Ess- bzw. Schneideflächen sind aufwändig poliert, eine hitzebeständige, griffige Silikon-Manschette hält das Besteck-Set praktischerweise bei Nichtbenutzung zusammen. Maße: 4 x 18,1 cm Hinweis: Nicht für den Wiederverkauf freigegeben.
226 097 29,95 1 ESBIT TASCHENKOCHER 19 95 2 ESBIT KOCHSETSPIRITUS79 95 3 ESBIT BESTECKSETTITAN29 95 klappbareSpiritusbrennerGriffe=kleinesPackmaß Silikon-ManschetteZusammenhaltenzum Für Töpfe, Becher und Pfannen geeignet
3 ESBIT TITAN-BESTECKSET






























aus recyceltemLeder HeizungsentlüfterHeizungsentlüfterpraktischer mitFlaschenöffner Lieferung nur für den gewerblichen Bedarf. Alle Preise zzgl. MwSt.14 | NEUHEITEN 1 NOTIZBUCH A5 AUS RECYCELTEM LEDER A5 Notizbuch aus recyceltem Leder mit elastischem Band zum Verschließen, Lesemarkierung und 160 linierten Seiten. Maße: 14 x 21 x 1,6 cm P Prägung. Fläche: Vorderseite 70 x 30 mm Preis/Stk.: ab 25 Stück 1,60 Werkzeugkosten: Siehe Serviceseiten. 226 503 braun ab 2,95 226 511 schwarz ab 2,95 1 NOTIZBUCH A5 AUS RECYCELTEM LEDER ab 2 95 STÜCKAB STÜCK-PREIS PRÄGUNG 1 4,95 25 4,75 1,60 50 4,55 1,20 100 4,25 -,95 250 3,95 -,75 500 3,45 -,60 1.000 2,95 -,50 Druckkosten weitere Farben: siehe Onlineshop 2 MITSCHLÜSSELANHÄNGERHEIZENTLÜFTERSCHLÜSSEL Die Heizung regelmäßig zu entlüften ist ein einfacher Weg seine Heizkosten zu senken. Dieses kleine Tool am Schlüsselring erweist dabei einen zuverlässigen Dienst. Maße: 6,2 x 3,2 x 1 cm L Lasergravur. Fläche: Vorderseite 20 x 10 mm Preis/Stk.: ab 60 Stück -,80 Werkzeugkosten: Siehe Serviceseiten. 226 144 ab 1,29 3 MITWAGENLÖSEREDELSTAHL-EINKAUFS-FLASCHENÖFFNER Mal wieder keinen Plastik-Chip oder Kleingeld zur Hand? Unser Einkaufswagenchip mit integriertem Kapselheber ist immer griffbereit und löst zuverlässig alle FrontladerEinkaufswagen. öffner.EinkaufswagenmünzeSchlüsselanhängerMultifunktionalerausEdelstahlmitundFlaschenMaße: 6 x 2,3 x 0,2 cm L Lasergravur. Fläche: auf einer Seite 25 x 8 mm Preis/Stk.: ab 200 Stück -,36 Werkzeugkosten: Siehe Serviceseiten. 226 714 ab -,39 2 MITSCHLÜSSELANHÄNGERHEIZENTLÜFTERSCHLÜSSEL ab 1 29 3 MITEDELSTAHL-EINKAUFSWAGENLÖSERFLASCHENÖFFNER ab 0 39 STÜCKAB STÜCK-PREIS GRAVURLASER1 2,19 60 1,99 -,80 150 1,89 -,75 300 1,79 -,70 600 1,59 -,65 1.500 1,39 -,60 3.000 1,29 -,50 Druckkosten weitere Farben: siehe Onlineshop STÜCKAB STÜCK-PREIS GRAVURLASER1 -,79 200 -,69 -,36 500 -,65 -,34 1.000 -,59 -,32 2.500 -,55 -,30 5.000 -,49 -,29 10.000 -,39 -,28 Druckkosten weitere Farben: siehe Onlineshop
































































226
Maße: 15,3 x
x
cm 226 370 5,95 3 PUSTEFIX KLASSIK 42 ML 25ER DISPLAY 24 95 2 TROMPETEMULTIPUSTEFIXBUBBLE 5 95 1 MULTIPUSTEFIXBUBBLER 9 95 MADE GERMANYIN
Die Trompete macht zwar keine Töne, dafür aber einen großen SeifenblasenRegen. Mit 250 ml Flasche, Flüssigkeitsschale und Multi-Trompete. Hinweis: Nicht für Kinder unter Jahren geeignet. 9,8 18,7
3
226 321 24,95 2 MULTIPUSTEFIXBUBBLE TROMPETE
Enthält:
BUBBLE-SPASS!ZAUBERHAFTER MEGA SEIFENBLASEN STÜCK25 Weihnachts-EditionaufSeite294 15NEUHEITEN | 1 PUSTEFIX MULTI BUBBLER
Heiß begehrt bei großen und kleinen Seifenblasen-Artisten: mit dem Set aus dem großen gelben Ring und dem blauen Multi-Ring bringt man nicht nur riesige Seifenblasen zum Fliegen, sondern kann ganze Seifenblasenskulpturen durch die Luft schweben lassen. 1 x großer Ring, 1 x Multi-Ring, 1 x Teller und 250 ml Nachfüllflasche. Hinweis: Nicht für Kinder unter 3 Jahren geeignet. 388 9,95 PUSTEFIX KLASSIK 42 ml, 25er Display 25 Stück der weltbekannten Klassiker von PUSTEFIX: die kleine Dose voller Spaß. Sofort pustebereit zum Träumen und Entspannen. Produkt enthält insgesamt 1,05 l. Hinweis: Nicht für Kinder unter 3 Jahren geeignet. Maße: 15 x 15 x 10 cm
3

















































EINZIGARTIG IN FORM UND FUNKTION: EIN ECHTER ALLROUNDER. Lieferung nur für den gewerblichen Bedarf. Alle Preise zzgl. MwSt.16 | NEUHEITEN
4 MIXEDEASYSHOPPINGBAGDOTSRED Lässt sich auf beiden Seiten über den Einkaufswagen einhängen und befüllen. Das Volumenwunder ersetzt mindestens drei Plastiktüten. Und das bei jedem Einkauf. Nach Gebrauch wird die Tasche aus hochwertigem, wasserabweisenden Polyestergewebe mit zwei stabilen Einhängestangen einfach zusammengerollt und der Extrahülle verstaut. Mit Griffpolstern an den Trageriemen und Reißverschluss-Innentasche mit 2 Einkaufswagen-Chips. Material: 100 % Polyester. Maße: 32,5 x 38 x 51 cm
3 MINI MAXI SHOPPER MIXED DOTS RED Winzig klein und bei Bedarf ganz groß. Der Mini Maxi Shopper zählt zu den Topstars von reisenthel und ist nun in einer neuen, optimierten Version erhältlich. Ein flexibles Band fi xiert die Tasche im zusammengelegten Zustand, mit den extralangen Tragehenkel kann der Shopper auch ganz lässig über der Schulter getragen werden. Aus hochwertigem, wasserabweisenden Polyestergewebe. Material: 100 % Polyester. Maße: 43,5 x 63 x 6 cm 226 407 5,95
2 MIXEDBOTTLEBAGDOTS RED Kein Klappern, kein Klirren. In der Bottlebag mit zwei reißfesten Trageriemen haben bis zu neun 1,5-LiterFlaschen ihr eigenes stoßgeschütztes Fach. Besonders praktisch: Das Bodenmaß ist auf handelsübliche Fahrradkörbe abgestimmt. So können Getränke auch komfortabel zu Partys und Events mitgenommen werden. Im neuen mixed dots red Design. Material: 100 % Polyester. Maße: 24 x 28 x 24 cm 226 415 11,95
226 423 19,95 1 CARRYBAG FRAME MIXED DOTS RED 45 95 3 MINI MAXI SHOPPER MIXED DOTS RED 5 95 2 MIXEDBOTTLEBAGDOTS RED 11 95 4 MIXEDEASYSHOPPINGBAGDOTSRED 19 95
1 CARRYBAG FRAME MIXED DOTS RED Ein echter Klassiker von reisenthel! Der Einkaufskorb – jetzt im „mixed dots red“ Design – hat einen stabilen Aluminiumrahmen, eine Innentasche mit Reißverschluss sowie einen festen Boden mit Standfüßen. Der Tragegriff ist weich ummantelt und lässt sich umklappen. Das wasserabweisende Gewebe ist aus recycelten PET-Flaschen. Und in den seltenen Fällen, in denen der Korb nicht gebraucht wird, lässt er sich flach und platzsparend zusammenlegen.
Material: 100 % Polyester. Maße: 48 x 29 x 28 cm 226
396 45,95




















UNDLANGLEBIGSTYLISCHUNTERWEGS 17NEUHEITEN | 4 TOILETBAG ab 19 95 1 CARRYBAG FRAME TWIST SKY ROSE Das wunderschöne, neue Dekor ‚twist sky rose‘, lädt zum Träumen ein. Graues Obermaterial aus recycelten PETFlaschen kombiniert mit romantischen, rosé goldenen Details. Perfekt um den Frühling einzuläuten, einen Stadtbummel zu machen oder mit der Familie einen Ausflug in die Natur zu planen. Twist sky rose für uns ganz groß! Maße: 48 x 29 x 28 cm 226 466 49,95 2 CASE MIXED1 DOTS RED Das Case 1 ist das Kosmetiktäschchen für unterwegs. Es ist ein wahres Platzwunder und passt in jede Handtasche. Maße: 24 x 17 cm 226 440 5,95 3 MIXEDMULTICASEDOTS RED Hätte Vielseitigkeit eine Farbe, wäre das Multicase von reisenthel ein Regenbogen: In Schule, Uni oder Büro macht es das Leben als Schlampermäppchen bunter. Als KosmetikNecessaire kommt es aufgeräumt praktisch daher. Maße: 21 x 10 x 7 cm 226 458 11,95 2 CASE MIXED1DOTS RED 5 95 3 MIXEDMULTICASEDOTS RED 11 95 1 CARRYBAG FRAME TWIST SKY ROSE 49 95 4 TOILETBAG Der Butler fürs Bad, der auch unterwegs für maximale Wohlfühlatmosphäre sorgt. Einfach aufhängen und aufklappen: ein großes Hauptfach mit vier zusätzlichen Steckfächern sowie zwei Reißverschlusstaschen im Deckel bieten Platz für sämtliche Flaschen und Tuben. Mit herausnehmbarem Spiegel. Aus hochwertigem, wasserabweisenden Polyestergewebe. Maße: 23 x 20 x 10 cm Material: 100 % Polyester SP Spezialdruck. Fläche: 140 x 100 mm Preis/Stk.: ab 7 Stück 3,95 Werkzeugkosten: Siehe Serviceseiten. 165 444 schwarz 19,95 226 431 mixed dots red 20,95

















1.DRUCKFARBE
2 HOLZ-KUGELSCHREIBER Kugelschreiber aus Holz mit blauschreibender Mine, silbernen Applikationen und einer Einkerbung am Schaft. S Siebdruck. Fläche: seitlich Klipp 40 x 14 mm Preis/Stk.: ab 75 Stück -,50 L Lasergravur. Fläche: seitlich Klipp 40 x 6 mm Preis/Stk.: ab 75 Stück -,70 Werkzeugkosten: Siehe Serviceseiten. 225 596 Wallnuss ab -,99 225 607 Buche ab -,99 METALLSCHREIBER SOFT TOUCH MIT TOUCH-PEN „SALT LAKE CITY“ Metall-Kugelschreiber mit rubber finish Oberfläche, Touch-Pen und blauschreibender Großraummine. S Siebdruck. Fläche: seitlich Klipp 50 x 13 mm Preis/Stk.: ab 150 Stück -,29 L Lasergravur. seitlich Klipp 40 x Preis/Stk.: ab Stück -,39 Werkzeugkosten: Serviceseiten. -,49 -,49 -,49 -,49
1 METALLSCHREIBER SOFT TOUCH MIT TOUCH-PEN „SALT LAKE CITY“ ab 0 49 2 HOLZ-KUGELSCHREIBER ab 0 99 3 ZABOXTOUCH-KUGELSCHREIBER ab 0 69
225 432 blau ab
5 mm
225 457 grün ab
Druckkosten5.0002.5001.00010011,45–1,25-,35-,552501,15-,30-,505001,05-,25-,45-,95-,20-,40-,75-,15-,35-,69-,10-,25weitereFarben:sieheOnlineshop
STÜCKAB STÜCK-PREIS 1.DRUCKFARBE GRAVURLASER-
1
225 449 rot ab
ZABOXTOUCH-KUGELSCHREIBER
225 473 schwarz ab -,49
150
STÜCKAB STÜCK-PREIS GRAVURLASER-
225 465 weiß ab
Touch-Kugelschreiber aus Aluminium mit mattem Finish. Griff aus Bambus. Blauschreibend. S Siebdruck. Fläche: seitlich Klipp 45 x 12 mm Preis/Stk.: ab 100 Stück -,35 L Lasergravur. Fläche: seitlich Klipp 50 x 6 mm Preis/Stk.: ab 100 Stück -,55 Werkzeugkosten: Siehe Serviceseiten. 224 899 weiß ab -,69 224 903 dunkelblau ab -,69 224 911 schwarz ab -,69 224 920 grau ab -,69
Siehe
Fläche:
Druckkosten5.0003.0001.0005001507511,89–1,79-,50-,701,69-,45-,651,59-,40-,601,39-,35-,551,19-,30-,50-,99-,20-,40weitereFarben:sieheOnlineshop
STÜCKAB STÜCK-PREIS 1.DRUCKFARBE GRAVURLASER-
Druckkosten5.0003.0001.000500150-,79-,29-,391-,89–-,75-,25-,35-,69-,22-,30-,59-,19-,25-,49-,15-,20weitereFarben:sieheOnlineshop
18 | NEUHEITEN
Lieferung nur für den gewerblichen Bedarf. Alle Preise zzgl. MwSt. 3

















































































IM BESTEN SINNE WERBEN FÜR IHRE KUNDEN UND DIE UMWELT GERMANYMADEUPIN 19NEUHEITEN | 1 SENATOR ® KUGELSCHREIBER EVOXX POLISHED RECYCLED Unverwechselbarer Recycling Superheld aus 100% R-ABS-Recycling-Material. Glänzend opake Gehäuseoberfläche und langlebige blauschreibende senator® magic flow G2 Mine (1,0 mm). S Siebdruck. Fläche: Schaft 30 x 14 mm Preis/Stk.: ab 200 Stück -,18 W Werbedruck. Fläche: Klipp 33 x 4 mm Preis/Stk.: ab 200 Stück -,18 Werkzeugkosten: Siehe Serviceseiten. D Digitaldruck. Fläche: seitlich 60 x 6 mm Preis/Stk.: ab 200 Stück -,45 Datenhandling: einmalig 29,225 481 weiß ab -,39 225 490 schwarz ab -,39 225 504 blau ab -,39 225 512 rot ab -,39 225 529 grün ab -,39 225 537 orange ab -,39 DRUCK4C STÜCKAB STÜCK-PREIS 1.DRUCKFARBE DIGITAL4C Druckkosten5.0003.0001.0005002001-,65–-,59-,18-,45-,55-,15-,37-,49-,12-,30-,45-,10-,25-,39-,09-,22weitereFarben:sieheOnlineshop 1 SENATOR® KUGELSCHREIBER EVOXX POLISHED RECYCLED ab 0 39











































DIE KÖNNEN SICH SEHEN LASSEN ÜBERALL SCHICK TRINKEN Lieferung nur für den gewerblichen Bedarf. Alle Preise zzgl. MwSt.20 | NEUHEITEN 1 GOLDENVAKUUM-TRINKFLASCHETASTE Doppelwandige Trinkflasche: außen und innen aus Edelstahl, silberner Deckel mit sicherem Schraubverschluß, Füllmenge: ca. 500 ml Maße: 26 x Ø 7 cm S Siebdruck. Fläche: rundum 170 x 60 mm Preis/Stk.: ab 15 Stück 2,20 W Werbedruck. Fläche: 25 x 70 Preis/Stk.:mmab 15 Stück 2,20 Werkzeugkosten: Siehe Serviceseiten. 224 796 silber ab 5,95 224 807 schwarz ab 5,95 224 815 weiß ab 5,95 224 823 blau ab 5,95 224 831 rot ab 5,95 224 840 grün ab 5,95 1 GOLDENVAKUUM-TRINKFLASCHETASTE ab 5 95 2 ALUMINIUM TRINKFLASCHE LOOPED Edle Trinkfl asche aus robustem Aluminium mit schickem transparentem Kunststoffdeckel mit Schraubverschluss, Silikonschlaufe, Füllmenge ca. 650 ml Maße: 23 x Ø 6,6 cm S Siebdruck. Fläche: rundum 170 x 60 mm Preis/Stk.: ab 35 Stück 1,10 W Werbedruck. Fläche: 20 x 70 Preis/Stk.:mmab 35 Stück 1,10 Werkzeugkosten: Siehe Serviceseiten. 224 858 blau ab 2,19 224 866 rot ab 2,19 224 874 schwarz ab 2,19 224 882 grün ab 2,19 STÜCKAB STÜCK-PREIS 1.DRUCKFARBE 1 8,25 15 7,95 2,20 50 7,45 1,75 100 7,25 1,50 200 6,95 -,90 400 6,45 -,70 800 5,95 -,50 Druckkosten weitere Farben: siehe Onlineshop STÜCKAB STÜCK-PREIS 1.DRUCKFARBE 1 3,65 35 3,35 1,10 100 3,15 -,99 200 2,95 -,89 500 2,75 -,79 1.000 2,45 -,69 2.500 2,19 -,49 Druckkosten weitere Farben: siehe Onlineshop 2 ALUMINIUM TRINKFLASCHE LOOPED ab 2 19








































BUNTER WIRD‘S NICHT FARBENFROHE WERBEARTIKEL IN HÖCHSTER QUALITÄT FARBENFROHE 21NEUHEITEN | 1 TASSE TWO TONES ab 1 99 1 TASSE TWO TONES Bedruckbare hochwertige Keramiktasse 330 ml. Farbige Innenwand. Insbesondere für Fotodrucke von höchster Qualität ist diese Tasse als Geschenk- oder Werbeartikel hervorragend geeignet. Spülmaschinengeeignet. Maße: 9,5 x Ø 8,3 cm SU Sublimationsdruck. Fläche: rundum 200 x 95 mm Preis/Stk.: ab 24 Stück 1,95 Werkzeugkosten: Siehe Serviceseiten. 224 665 rot ab 1,99 224 673 schwarz ab 1,99 224 681 hellblau ab 1,99 224 690 kobaltblau ab 1,99 224 704 altrosa ab 1,99 224 712 dunkelgrün ab 1,99 224 729 hellgrün ab 1,99 224 737 goldgelb ab 1,99 224 745 himmelblau ab 1,99 224 753 hellgelb ab 1,99 224 761 orange ab 1,99 224 770 bordeaux ab 1,99 STÜCKAB STÜCK-PREIS SUBLIMATION4C 1 3,59 24 3,25 1,95 48 3,15 1,75 96 2,95 1,65 192 2,75 1,45 288 2,45 1,25 576 2,25 1,10 1.152 2,10 1,05 2.304 1,99 -,99 Farbenfroher Druck in kleiner Auflage möglich





























































UPUP Lieferung nur für den gewerblichen Bedarf. Alle Preise zzgl. MwSt.22 | NEUHEITEN 1 FLASCHENÖFFNER RECYCLING Besonders stabiler Flaschenöffner aus 100 % recyceltem Kunststoff. Maße: 9,3 x 4,1 x 1,2 cm W Werbedruck. Fläche: vorne 40 x 25 mm Preis/Stk.: ab 150 Stück -,25 Werkzeugkosten: Siehe Serviceseiten. D Digitaldruck. Fläche: vorne 38 x 33 mm Preis/Stk.: ab 150 Stück -,60 Datenhandling: einmalig 29,225 658 weiß ab -,49 225 666 grau ab -,49 225 674 blau ab -,49 225 682 rot ab -,49 2 ZETTELBOX RECYCLING Kubus aus 100 % recyceltem Kunststoff mit ca. 900 weißen Blättern. Maße: 10,5 x 10,5 x 9 cm W Werbedruck. Fläche: links, rechts, hinten 80 x 80 mm Preis/Stk.: ab 50 Stück -,90 Werkzeugkosten: Siehe Serviceseiten. für Werbedruck 225 699 weiß ab 2,49 225 703 grau ab 2,49 225 711 blau ab 2,49 225 720 rot ab 2,49 ohne Werbedruck 225 914 weiß ab 2,49 225 922 grau ab 2,49 225 939 blau ab 2,49 225 947 rot ab 2,49 3 PAPIER MEMO SET Papier-Memo-Set mit Notizblock, Haftnotizen, Karton und Kunststoffstift. 50 Blatt pro Memo-Farbe. Die ersten fünf Seiten des Notizblocks sind mit einem Wochenplaner bedruckt, die anderen verbliebenen Seiten sind blanco. Maße: 31,0 x 17,4 x 0,8 cm W Werbedruck. Fläche: Kopflasche 120 x 25 mm Preis/Stk.: ab 50 Stück -,70 Werkzeugkosten: Siehe Serviceseiten. 225 640 1,69 DRUCK4C STÜCKAB STÜCK-PREIS 1.DRUCKFARBE DIGITAL4C 10.0005.0002.5001.0004001501-,95–-,85-,25-,60-,75-,22-,55-,70-,20-,50-,65-,18-,45-,55-,16-,40-,49-,14-,30DruckkostenweitereFarben:sieheOnlineshop STÜCKAB STÜCK-PREIS DRUCK 1. FARBE 3 SEITEN 5013,993,85 -,90 100 3,75 -,75 300 3,45 -,69 500 2,95 -,55 1.000 2,49 -,49 Druckkosten weitere Farben: siehe Onlineshop 1 RECYCLINGFLASCHENÖFFNER ab 0 49 2 ZETTELBOX RECYCLING ab 2 49 STÜCKAB STÜCK-PREIS 1.DRUCKFARBE 1 2,85 50 2,45 -,70 100 2,25 -,65 250 2,05 -,60 500 1,95 -,50 1.000 1,75 -,40 2.500 1,69 -,30 Druckkosten weitere Farben: siehe Onlineshop 3 PAPIER MEMO SET ab 1 69 UP Druck auf alle 3 Seiten MADE GERMANYGERMANYINMADEIN




















































































































































RINGRECYCLINGEINKAUFSWAGENLÖSERMITSCHLÜSSELNach Auslösen des Einkaufswagens herausziehbar. EK-Löser aus ca. 100 % recyceltem Kunststoff, mit Gliederkette und Schlüsselring aus Metall. Maße: 4,8 x 2,5 cm W Werbedruck. Fläche: 30 x 8 mm Preis/Stk.: ab 250 Stück -,20 Werkzeugkosten: Siehe Serviceseiten. 225 738 ab -,19 Trinkflasche aus recyceltem PET mit auslaufsicherem Verschluss, Karabinerhaken und einem Füllvermögen von 400 ml. Maße: 17,5 x Ø 6,5 cm W Werbedruck. Fläche: seitlich 20 x 70 mm Preis/Stk.: ab 50 Stück -,90 Werkzeugkosten: Siehe Serviceseiten. 225 393 blau ab 1,59 225 408 rot ab 1,59 225 416 grün ab 1,59 225 424 orange ab 1,59 AUS
UP 23NEUHEITEN | 3
2 „MECHELEN“RPET-FLASCHE
1 GYM-COTTONBAG
RECYCELTER BAUMWOLLE Oeko-Tex® STANDARD 100 zertifizierter Gym-Cottonbag aus recycelter Baumwolle. Grammatur 140g/m². Maße: 40 x 52 cm SP Spezialsiebdruck. Fläche: 240 x 200 Preis/Stk.:mmab 50 Stück -,85 Werkzeugkosten: Siehe Serviceseiten. 225 545 schwarz ab -,99 225 553 blau ab -,99 225 561 rot ab -,99 225 570 natur ab -,99 STÜCKAB STÜCK-PREIS 1.DRUCKFARBE 1 -,45 250 -,39 -,20 500 -,34 -,18 1.000 -,32 -,16 3.000 -,28 -,15 10.000 -,25 -,13 20.000 -,19 -,10 Druckkosten weitere Farben: siehe Onlineshop 3 RINGRECYCLINGEINKAUFSWAGENLÖSERMITSCHLÜSSELab 0 19 STÜCKAB STÜCK-PREIS 1.DRUCKFARBE 1 1,79 50 1,69 -,85 100 1,59 -,75 200 1,49 -,65 300 1,29 -,55 500 1,19 -,45 1.000 -,99 -,40 Druckkosten weitere Farben: siehe Onlineshop 1 GYM-COTTONBAG AUS RECYCELTER BAUMWOLLE ab 0 99 2 „MECHELEN“RPET-FLASCHE ab 1 59 UP STÜCKAB STÜCK-PREIS 1.DRUCKFARBE 1 2,59 50 2,39 -,90 100 2,19 -,80 250 1,99 -,70 500 1,79 -,60 1.500 1,69 -,50 3.000 1,59 -,40 Druckkosten weitere Farben: siehe Onlineshop























































































































































































NIE MEHR LANGEWEILE FÜR IHRE KLEINEN UND GROSSEN KUNDEN MIT DIESER MEGA AUSWAHL AN SPIEL & SPASS STÜCK20 STÜCK12 STÜCK12 Lieferung nur für den gewerblichen Bedarf. Alle Preise zzgl. MwSt.24 | NEUHEITEN 2 COMIC TIERPUZZLE 1 Set / 20 Stück Der Hit für unsere kleinen Puzzle-Fans. Vier liebevolle Comic-Tiermotive zeigen diese Kinderpuzzles. Jedes Puzzle besteht aus 12 Teilen. Maße: 13,5 x 10 cm Hinweis: Nicht für Kinder unter 3 Jahren geeignet. 225 117 12,95 2 COMIC TIERPUZZLE 12 95 1 HOLZ JO-JO MIT GLITZER 1 Set / 12 Stück Geschick, Übung und Geduld sind gefragt: mit den Jo-Jos aus Holz lassen sich coole Tricks zaubern. Schöne Motive für alle. Aufwändig verarbeitet mit Glitzersteinapplikationen. Sortiert. Maße: Ø ca. 5 cm Hinweis: Nicht für Kinder unter 3 Jahren geeignet. 225 125 12,95 1 HOLZ JO-JO MIT GLITZER 12 95 3 STACHEL FLUMMIS 1 Set / 12 Stück In welche Richtung hüpft der kunterbunte Stachel-Flummi? Durch seine überraschende Sprungkraft ist es ein buntes Vergnügen für jeden. Da sind Spaß und Action garantiert. Maße: Ø ca. 4,5 cm Hinweis: Nicht für Kinder unter 3 Jahren geeignet. 225 133 12,95 3 STACHEL FLUMMIS 12 95




































































































































































































3 WIKINGER WURFSPIEL KUBB Kubb oder auch oft Wikingerschach genannt, ist ein Outdoor-Geschicklichkeitsspiel für 2 bis 12 Spieler. Der Name Kubb kommt von Kubbar oder Holzklotz auf Schwedisch. Diese sind aus FSC zertifiziertem Holz: 1 König, 4 Eckpfosten, 10 Holzblöcke und 6 Wurfhölzer, inkl. Bio-Baumwollbeutel und Spielanleitung. Maße: 27 x 20,5 x 9,5 cm Hinweis: Nicht für Kinder unter 3 Jahren geeignet. 224 788 16,95 1 MATCHBOX AUTOS 1 Set / 12 Stück Egal, ob auf einer gemütlichen Fahrt durch die Stadt, auf der Fahrt zum Rettungseinsatz oder bei Vollgas in Richtung nächstes Abenteuer – diese Fahrzeuge bieten stundenlangen Spielspaß, bei dem der Fantasie keine Grenzen gesetzt sind. Lieferung erfolgt sortiert. Die Modelle variieren je nach Verfügbarkeit. Maße: 10,5 x 10,5 x 3 cm Hinweis: Nicht für Kinder unter 3 Jahren geeignet. 184 19,95 1 MATCHBOX AUTOS 19 95 2 SCHMIDT BRINGSEL 1 Set / 6 Stück So eine längere Reise kann schon mal schnell langweilig werden. Gerade die kleinen Fahrgäste wollen beschäftigt und abgelenkt werden. Mit diesem 6er-Set an Spieleklassikern, vergeht jede längere Zug- oder Autofahrt im Nu! Jeweils in praktischer Metallbox. Maße: je Spiel 10 x 7 x 3,3 cm Hinweis: Nicht für Kinder unter 3 Jahren geeignet. 192 16,95 SCHMIDT BRINGSEL 16 95 WIKINGER WURFSPIEL KUBB 16 95
225
Die hier abgebildeten Autos sind Beispiele, die Modelle variieren Länge ca. 25 cm
2
3
UMWERFEND TOLL STÜCK12 STÜCK6 25NEUHEITEN |
225















































































































































































































































STÜCK24STÜCK50 144STÜCK Lieferung nur für den gewerblichen Bedarf. Alle Preise zzgl. MwSt.26 | VIELNEUHEITENFREUDE SCHENKEN IDEAL ALS MITGEBRINGSEL, FÜR DEN SCHULANFANG ODER GASTGESCHENK IN DER PRAXIS 3 GEDULDSPIELE TIERCHEN 1 Set / 24 Stück Niedliche kleine Hunde, Pandabären, Hasen & Co. sorgen für jede Menge Spaß und Spannung, denn das kleine Metallkügelchen muss vorsichtig den richtigen Weg finden. Sortiert. Lieferung erfolgt im Polybeutel. Maße: Ø ca. 6,5 x 5 cm Hinweis: Nicht für Kinder unter 3 Jahren geeignet. 225 168 10,95 3 GEDULDSPIELETIERCHEN 10 95 1 BUNTE FLUMMIS 1 Set / 50 Stück Alle Kids lieben Flummis. Diese bunt gemischten Springbälle mit tollen Sprungeigenschaften passen in jede Hosentasche und sind so immer griffbereit. Lieferung erfolgt im Polybeutel. Maße: Ø ca. 2,7 cm Hinweis: Nicht für Kinder unter 3 Jahren geeignet. 225 094 10,95 1 BUNTE FLUMMIS 10 95 2 RADIERGUMMIS SMILE 1 Set / 144 Stück Kleine Radiergummis mit lachenden Gesichtern machen kleine Fehlerchen schnell vergessen und zaubern ein Lächeln auf‘s Gesicht. Vielfach sortiert. Lieferung erfolgt im Polybeutel. Maße: Ø ca. 2,6 cm Hinweis: Nicht für Kinder unter 3 Jahren geeignet. 225 150 19,95 2 RADIERGUMMIS SMILE 19 95






















































































































































































In einer wunderbar lustigen Aufmachung kommen diese wunderschönen Seifenblasen-Meerestiere mit Umhängekordel daher. Ein immer wieder beliebter Zugabeartikel für alle Kids. Sortiert. Lieferung im Display. Maße: Ø ca. 7,5 cm Hinweis: Nicht für Kinder unter 3 Jahren geeignet. 225 176 19,95 |
4 MEGA BÄLLE SMILE 1 Set / 30 Stück Spiel, Spaß und Freude! Die bunten Mega-Bälle lachen sich in jedes Kinderherz. Sie sind perfekt geeignet für kleine Kinderhände und lassen sich super greifen. Außerdem sind sie formstabil, geben nach und kehren leicht in die ursprüngliche Form zurück. Maße: Ø ca. 6 cm Hinweis: Achtung: keine Flummis und daher auch für Kleinkinder ab 2 Jahren geeignet 109 16,95 MEGA BÄLLE SMILE 16 95 UND BASTELKNETE Set / 12 Stück Egal ob basteln, modellieren oder zu einem Ball geformt hüpfen lassen: mit dieser bunten Knete sind der Phantasie keine Grenzen gesetzt. Maße: Ø ca. 6,5 cm Hinweis: Nicht für Kinder unter 3 Jahren geeignet. 225 086 10,95 GEWINN MIT 4 SPIEL 1 Set / 10 Stück Waagerecht, senkrecht oder diagonal: Das knifflige Duell um „Vier in einer Reihe“ beginnt! Ein toller Begleiter, auch für unterwegs. Maße: ca. 8 x 6,8 cm Hinweis: Nicht für Kinder unter 3 Jahren geeignet. 225 141 7,95 95
27NEUHEITEN
1 HÜPF-
225
4
LUSTIGE BESCHÄFTIGUNG EGAL, OB FÜR UNTERWEGS, IM BÜRO ODER ZUHAUSE, in tollen NEON-FarbenSTÜCK12
2 GEWINN MIT 4 SPIEL 7 95 3 MEERESTIERESEIFENBLASEN 19
1 HÜPFBASTELKNETEUND 10 95 2
1
3 SEIFENBLASEN MEERESTIERE 1 Set / 24 Stück
STÜCK24





















































































































































































































































praktische Schlaufe für den Gürtel den gewerblichen Bedarf. FLEECE „DOVE“ M Diese Hundedecke ist eine besonders softe und flauschige Decke für den Hund. Perfekt als Unterlage für all die erlaubten und nicht immer erlaubten Plätze, an denen der Hund in der Regel keine Haare hinterlassen sollte wie Bett, Couch, Auto oder in seinem Hundebett. LECKERLI BEUTEL WASCHBARES PAPIER, SCHIEFER Ob als praktische Tasche für Snacks beim Hundespaziergang oder für Herrchen und Frauchen auf Reisen: Der Leckerli Beutel aus waschbarem Papier bietet unendlich viele Einsatzmöglichkeiten
Alle Preise zzgl. MwSt.28 | NEUHEITEN HOHE QUALITÄT FÜR ALLE, DIE FÜR IHRE FELLNASEN NUR DAS BESTE WOLLEN 3 CLOUD7
Lieferung nur für
BLUE
HUNDEDECKE
und einen gezielt minimalistischen Look. Eine stabile und dennoch knautschige Haptik sowie durchdachte Details wie eine Schlaufe zur Befestigung am Gürtel runden diese absolut zeitgemäße Leckerli Tasche ab. Material: Papier Maße: 15 x 10 x 5 cm 225 248 5,95 1 CLOUD7 HUNDESPIELZEUG „LOVE BONE“ weißer Plüsch Der Traum eines jeden Hundes: der Knochen der niemals zu Ende geht. Der lustige Spielknochen LOVE BONE fühlt sich nicht nur sehr flauschig im Maul an, er macht auch zusätzlich einen hübschen Quietsch-Laut. Material: organische Baumwolle Maße: 21 x 18 cm 225 256 16,95 2 LECKERLI BEUTEL 5 95 3 FLEECE „DOVE“HUNDEDECKE 34 95 1 „LOVEHUNDESPIELZEUGBONE“ 16 95
Maße: 80 x 63 cm 225 221 34,95 2 CLOUD7































Einfach auf die Hundemahlzeit sprühen rutschfesterBoden Einzelpersonalisierung/Lasergravur 29NEUHEITEN | GUTES FÜR DEN HUND 1 CLOUD7 HUNDENAPFEDELSTAHLDYLAN Der elegant minimalistische Hundenapf Dylan kommt in einem besonders puren Design daher: Nur eine dezente Logo-Gravur sowie ein mattes Finish innen vollenden den glänzenden Napf in seiner runden, ästhetischen Form. Besonders praktisch wird der Hundenapf durch seine pflegeleichten Eigenschaften sowie einen rutschfesten Boden. Material: Edelstahl 225 205 Größe S Ø 14 cm / 0,5 l 17,95 225 213 Größe M Ø 16 cm / 0,8 l 19,95 auch mit Einzelpersonalisierung / Lasergravur erhältlich 225 264 Größe S Ø 14 cm / 0,5 l 22,95 225 272 Größe M Ø 16 cm / 0,8 l 24,95 1 DYLANHUNDENAPFEDELSTAHL ab 17 95 2 CLOUD7 JUTE NAPFUNTERLAGE NATURAL/BLACK M Diese in Handarbeit gefertigte Napfunterlage vermeidet nicht nur Tropfen und Futterreste auf dem Fußboden, sondern verleiht dem Wohnraum zudem einen besonders gemütlichen Touch. Jeder einzelne Napfuntersetzer wird aus natürlichen Materialien kunsthandwerklich hergestellt und von Hand gefärbt. So wird jedes Stück zum Unikat und jede Mahlzeit für Ihren Hund noch schöner. Material: 100% Jute Maße: 60 x 38 cm 225 230 24,95 3 PETIZERS FUTTERÖL MIT GESCHMACK 150 ml Sprühflasche Futteröl neu gedacht! PETIZERS ist das Nahrungsergänzungsmittel für wählerische Hunde zum Aufsprühen. Mit Gourmet-Rezepturen in drei Geschmacksrichtungen verwandelt es jedes Futter in ein unwiderstehliches Festmahl. Dank schonend kaltgepresster nativer Öle ist das Flavor Spray besonders reich an wichtigen Mineralstoffen, Vitaminen sowie den ungesättigte Fettsäuren Omega 3 und 6. Für schönes Fell und ein gesundes Herz. 100% vegan, allergenfrei. Made in Germany. Maße: 5,5 x 5,5 x 16 cm 225 289 Roastbeef 17,95 225 297 Bergkäse 17,95 225 301 Prosciutto 17,95 2 NAPFUNTERLAGEJUTE 24 95 3 PETIZERS FUTTERÖL MIT GESCHMACK 17 95 MADE GERMANYINVEGAN TEP FREE




































































































natürliche Zutaten Lieferung nur für den gewerblichen Bedarf. Alle Preise zzgl. MwSt.30 | NEUHEITEN 3 7 TAGE NOTVORRAT Ob Not-, Expeditions- oder OutdoorVorrat, mit diesem Paket liegen Sie sicher und richtig. Alle Zutaten müssen nur noch mit heißem Wasser zubereitet werden und sind abwechslungsreich und lecker. Packungsinhalt: 2 x EF Karotteneintopf (125g), 2 x EF Kartoffel-Kerbel-Topf (125g), 3 x EF Erbseneintopf (115g), 2 x EF Kartoffeleintopf (110g), 3 x EF Linseneintopf (115g). Mindestens 10 Jahre haltbar. 225 027 59,00 1 DOSENBISTROVORRATSDOSE Ob Hausbrot, Marmorkuchen oder Cookies, diese über 10 Jahre haltbare Reserve ist sofort verzehrfertig. BPAfreie Verpackung. 224 954 Hausbrot mischbrotVollkorn-385g 5,95 224 962 370Marmorkucheng 7,95 224 979 CookiesMini-MüsliKeksdose225 g 7,95 2 CONVARVORRATSDOSE Konservendosen bieten viele Vorteile: sie brauchen keine Kühlkette, die Lagerung ist denkbar einfach und energiearm, die Dosen sind robust, leicht zu öffnen & sehr lange haltbar. Die Feldküche von Convar setzt noch einen darauf: es schmeckt lecker. 224 987 (400Gulascheintopfg) 5,95 224 995 (400Kartoffeleintopfg) 5,95 4 FELDKÜCHEVORRATSRESERVECONVAR FLEX (gefriergetrocknet) Gefriergetrocknete Gerichte sind platzsparend und lassen sich einfach zubereiten: 250 ml Wasser zufügen, 10 min. durchziehen 225 002 (60Erbseneintopfg) 2,95 225 019 Karotteneintopf(60g) 2,95 Ein guter Notvorrat ist ebenso wie gewappnet.SodenbietensicherenBausteinungenFeuerlöscherVerbandskasten,undVersicher-einunverzichtbarerineinemzukunfts-Vorsorgekonzept.WirdaherallesrundumindividuellenVorratan.istmanfüralleFällegut 1 DOSENBISTRO ab 5 95 2 CONVARVORRATSDOSE 5 95 4 FELDKÜCHEVORRATSRESERVEFLEX 2 95 3 7 TAGE NOTVORRAT 59 .MIT DIESEN EXTRA LANG RICHTIGGARANTIERTLIEGENLEBENSMITTELNHALTBARENSIE Kartoffeleintopf Gulascheintopf 10 Jahre haltbar Mindestens 10 Jahre haltbar Mindestens haltbar bis: 04/2033



















































IM3SET GRAMM125 LITER15 MADE GERMANYIN MADE GERMANYIN 31NEUHEITEN | 3 INSTURMSTREICHHÖLZERDOSE Windfeste und wasserfeste Sturmstreichhölzer, perfekt für alle OutdoorFans. Die kleine wasserdichte Plastikdose mit Schraubverschluss hat eine Reibefläche auf dem Deckel. Mit dem extra langen Schwefelkopf brennen die Hölzer auch bei starkem Wind. Maße: 5,2 x Ø 3 cm Hinweis: Nicht für Kinder unter 12 Jahren geeignet. 225 344 4,95 AUF SICHERNUMMERGEHEN 1 WASSERTANK FALTBAR 15 LITER Praktischer Wassertank aus Kunststoffmaterial mit kombiniertem Auslaufhahn / Drehverschluss und einem Fassungsvermögen von 15 Litern. Lebensmittelecht. Material: 100% Polyethylen Maße: 25 x 25 x 25 cm 225 352 14,95 2 BUNDESWEHR HARTKEKSE Jeder, der viel in der Natur unterwegs ist, braucht zwischendurch etwas für den kleinen Hunger. Die Original Bundeswehr Hartkekse sind die ideale Wegzehrung für unterwegs. Die süßlich schmeckenden Energielieferanten sind lange haltbar und fallen kaum ins Gewicht. Made in Germany. Inhalt : 12 Kekse, 125 g Maße: 17 x 6 x 5 cm 225 336 3,49 4 STABKERZENSet/3Stk. Stabkerzen gehören in jedem Haushalt nicht nur aus romantischen Gründen zur Standardausrüstung: Sie bringen Licht ins Dunkel, auch wenn es mal kein Strom gibt. Langbrennende Qualitätskerzen Made in Germany. Maße: 20 x Ø 2,3 cm 225 310 1,95 1 FALTBARWASSERTANK 14 95 2 HARTKEKSEBUNDESWEHR 3 49 3 INHÖLZERSTURMSTREICH-DOSE 4 95 4 STABKERZEN 1 95 MIT JEDESINDVORRÄTENDIESENSIEAUFSITUATIONVORBEREITET































































































































































3 LED-DYNAMO TASCHENLAMPE Taschenlampe mit Dynamo-Funktion. Diese LED-Dynamotaschenlampe aus Kunststoff, mit Handschlaufe ist in zwei Farben erhältlich. Ein praktischer Alltagshelfer der ihren Werbeaufdruck zum leuchten bringt. Dank Kunststoffgehäuse ist die LED Dynamo Taschenlampe vor Spritzwasser geschützt. In leuchtenden Farben (rot/ blau) fällt die Lampe überall auf und ist auch in der Dämmerung gut zu finden. Der perfekte Survival Artikel für Abenteurer und Outdoorfans. Maße: 10 x 5,1 x 2,6 cm W Werbedruck. Fläche: seitlich 50 x 20 mm Preis/Stk.: ab 70 Stück -,45 Werkzeugkosten: Siehe Serviceseiten. 223 988 rot ab 1,19 223 996 blau ab 1,19 1
Das tragbare Duronic Hybrid Radio ist ein einzigartiges AM / FM Radio mit integriertem 300 mAh Batterieladegerät. Dank der Dynamokurbel, der Sonnenkollektoren oder des USB (Kabel wird mitgeliefert) wird die eingebaute Batterie umweltschonend aufgeladen. Dieses Outdoor-Radio ist der perfekte Begleiter für Wanderungen, Picknicks, Campingausflüge, Zuhause, Garten oder Werkstatt. Maße: 13 x 7,3 x 4,1 cm 224 018 15,95
2 DURONIC HURRICANE LAMPE MIT KURBEL
Die Duronic Hurricane Lampe ist das perfekte Produkt, um Sie im Dunkeln zu begleiten, unabhängig von Ihrer Situation (Ausflüge, Unfall, Stromausfall etc.). Der Vorteil dieses Modells ist, dass Sie dieses Produkt dank seiner Kurbel von Hand und über einen USB-Anschluss nachladen können. Mit der gespeicherten Energie können Sie sogar in Notfallsituationen die Lampe als 300 mAh Powerbank für Ihre wichtigsten Geräte verwenden. 2 Beleuchtungsmodi sowie SOS-Modus. Maße: 18,5 x Ø 12 cm 224 000 19,95
1 MITHYBRIDDURONICRADIOKURBEL 15 95 2 HURRICANEDURONIC LAMPE MIT KURBEL 19 95 3 TASCHENLAMPELED-DYNAMO ab 119 STÜCKAB STÜCK-PREIS 1.DRUCKFARBE 1 1,85 70 1,75 -,45 150 1,65 -,40 300 1,55 -,35 1.000 1,35 -,30 2.000 1,19 -,25 Druckkosten weitere Farben: siehe Onlineshop
DURONIC HYBRID RADIO MIT KURBEL
Inkl.DynamokurbelInkl.Dynamokurbel Lieferung nur für den gewerblichen Bedarf. Alle Preise zzgl. MwSt.32 | IMNEUHEITENFALLE EINES FALLES BLEIBEN SIE DYNAMISCH














2 EMISSIMO TEC SOLARRADIO MIT KURBEL Dieser Alleskönner ist immer einsatzbereit. Oft liegen Taschenlampen in Schubladen und wenn man sie wirklich braucht, ist die Batterie leer. Nicht bei diesem Gerät! Den Akku (4.000 mAh, Lithium-Polymer) können Sie per USB oder über die eingebaute Solarzelle laden. Mit der eingebauten Kurbel können Sie, wie bei einem Fahrrad-Dynamo, Strom erzeugen. Das eingebaute UKW-Radio (AM/FM/NOAA-Wetterband) hilft Ihnen dabei, informiert zu bleiben. Weitere Merkmale: Wasserfest IPX3, SOS-Alarm, Leselampe, Bewegungssensor, inkl. Ladegerät. UND
DAS SCHAFFT EIN GEFÜHL VON SICHERHEIT
Betrieben. Der
4-Takt-Benzinmotor ermöglicht eine konstante Leistung, ausgereifte Sicherheitstechnik mit Überlast- und Ölmangelschutz den sicheren Betrieb und pannenfreie Räder sowie ein klappbarer Schubbügel einen einfachen Transport des bedienerfreundlichen Gerätes. Besonderheiten • Betriebszustandsanzeige • Gleichstromausgang (12 V) • Schutzklasse IP 23 • Ölmangel- und Überlastschutz • Kraftstoffanzeige • Steckdose 1-phasig Typ F (Schuko) • Automatischer Spannungsregler (AVR) Maße: 64,5 x 62,2 x 54,9 cm, Gewicht ohne Zubehör 51,7 kg 224 059 599,1 KÄRCHER AGGREGATNOTSTROM-PGG3/1 599.-
2 EMISSIMO kommunalen zuverlässige
ÜBERALL EINSATZBEREIT
FernAbblendlichtund Antenne Handkurbel Solarpanel Leseleuchte 33NEUHEITEN |
223 961 54,95 IMMER
TEC SOLARRADIO MIT KURBEL 54 95 1 KÄRCHER AGGREGATNOTSTROM-PGG3/1 Kompakter, sehr mobiler und gleichzeitig leistungsstarker Synchrongenerator PGG 3/1 mit 2,8 kW Leistung zur autarken Stromversorgung beispielsweise auf Baustellen, in der Landwirtschaft oder in

























2 NOTFALLSET ab 13 95 Lieferung nur für den gewerblichen Bedarf. Alle Preise zzgl. MwSt.34 | NEUHEITEN 2 NOTFALLSET Ob unterwegs im Auto oder im Alltag, in diesem praktischen Etui finden Sie alles was zur schnellen ersten Hilfe benötigt wird. Das Notfallset besteht aus Dynamo-Taschenlampe, Aluminiumdecke, 2 Sicherheitsnadeln, Schere, 8 Desinfektionstüchern, 15 Pflastern, 4 Reinigungstüchern, 2 Mullbinden, Kreppband, Bandage, 2 Wundauflagen und Warnweste. Maße: 14,5 x 8 x 3,2 cm SP Fläche:Spezialsiebdruck 130 x 40 mm auf Etui Preis/Stk.: ab 8 Stück 4,50 Werkzeugkosten: Siehe Serviceseiten. 223 970 ab 13,95 STÜCKAB STÜCK-PREIS 1.DRUCKFARBE 1 17,95 8 16,95 4,50 3015,95 2,50 100 14,95 1,50 20013,95 1,30 Druckkosten weitere Farben: siehe Onlineshop 1 RPET TASCHE FÜR E-AUTO LADEKABEL Jeder E-Autofahrer kennt das Problem mit dem Elektro-Ladekabel: es wird irgendwo im Kofferraum oder im hinteren Fußraum hastig verstaut. Diese praktische und umweltfreundliche Kabeltasche für E-Auto-Ladekabel verschafft endlich Ordnung. Material: Polyester 600D RPET Maße: ca. 12 x 39 cm SP Spezialsiebdruck. Fläche: 240 x 160 mm Preis/Stk.: ab 15 Stück 2,90 Werkzeugkosten: Siehe Serviceseiten. 224 946 ab 4,95 1 RPET TASCHE FÜR E-AUTO abLADEKABEL 4 95 USE STÜCKAB STÜCK-PREIS 1.DRUCKFARBE 1 7,95 15 7,25 2,90 30 6,95 1,50 100 6,45 1,20 200 5,95 -,90 500 4,95 -,70 Druckkosten weitere Farben: siehe Onlineshop Ladekabel nicht enthalten





































































inkl.gratisRucksackRucksack 35NEUHEITEN | 1 ERSTE HILFE RUCKSACK Ob auf Wanderungen, Mountainbike-Touren oder Reisen in die Wildnis – in abgelegenen unbekanntem Terrain kann schnell eine Notfallsituation entstehen. Wer sich ins unbekannte Gelände begibt, weiß wie wichtig gute Vorbereitung und Vorsorge sind, denn das Unerwartete ist ein Naturgesetz. Mit diesem Erste-Hilfe-Rucksack haben Sie den entscheidenden Vorteil, für Vieles gewappnet zu sein. Maße: ca. 53 x Ø 20 cm • Erste-Hilfe-Set • 5 x Regenponcho • Multifunktionswerkzeug • Decke • 2 x Alu Becher • Trinkflasche 650 ml • Sturmstreichhölzer • Stabkerzen • Hybrid Radio mit Kurbel • 2 x Zahnbürste • Hartkekse • Dynamolampe 224 938 69,00 1 ERSTE HILFE RUCKSACK 69.- FÜRFÄLLEALLE













































































































































































































































































DRUCK!EINEMMITWELTDIESERFARBENALLENUR Lieferung nur für den gewerblichen Bedarf. Alle Preise zzgl. MwSt.36 | NEUHEITEN 29EINMALIGNUR .-VORKOSTEN



SUPER PREMIUM T-SHIRT „FRUIT OF THE LOOM“ ab 9 95 37NEUHEITEN | STÜCKAB INKL.STÜCKPREISDRUCK 8 14,95 25 13,95 50 12,95 100 9,95 SUPER PREMIUM T-SHIRT „FRUIT OF THE LOOM“ Klassisches Super Premium Unisex T-Shirt. Mit Rundhalsausschnitt. Kurzarm. Qualität: 100% Baumwolle, 3% Polyester. Weiß: 190 g/m 2, Schwarz: 205 g/m 2 D Fläche:Digitaldruck. 270 x 270 mm auf Brust oder Preis/Stk.:Rücken. Vorkosten:inklusiveeinmalig 29,weiß 190 g ab 9,95 schwarz 205 g ab 9,95 GRÖSSE SCHWARZ WEISS M 227 081 227 049 L 227 090 227 057 XL 227 104 227 065 XXL 227 112 227 073













inTeabagökologischer WEIL DIE kleinen Schri�e ZÄHLEN 1 USB STICK GREENCARD KEY Drucken Sie Ihre Werbebotschaft auf diesem kleinen Stück Pappe, das ein echtes Speicherwunder ist. Der Körper des USB-Sticks aus reinem, braunen Kraftkarton ist ökologisch nachhaltig. Dank COB Chip Technologie ist der USBStick außerdem enorm flach und leicht. Wahlweise mit 16 oder 32 GB Maße: 5,8 x 2,8 x 0,3 cm Hinweis: Die GEMA-Gebühren für USB-Sticks sind in unseren Verkaufspreisen enthalten und werden abgeführt. W Werbedruck. Fläche (16 GB): 30 x 13 mm Preis/Stk.: ab 20 Stück 1,75 W Werbedruck. Fläche (32 GB): 30 x 13 mm Preis/Stk.: ab 15 Stück 2,Werkzeugkosten: Siehe Serviceseiten. 210 484 16 GB ab 4,95 210 492 32 GB ab 5,95 1 USB STICK GREENCARD KEY ab 4 95 STÜCKAB STÜCK-PREIS 1.DRUCKFARBE 1 7,55 20 7,35 1,75 50 7,15 1,35 100 6,95 -,85 250 5,95 -,65 500 5,45 -,45 1.000 4,95 -,35 Druckkosten weitere Farben: siehe Onlineshop 16 GB: STÜCKAB STÜCK-PREIS 1.DRUCKFARBE 1 8,95 15 8,75 2,30 8,45 1,85 100 7,95 -,85 250 7,45 -,65 500 6,95 -,45 1.000 5,95 -,35 Druckkosten weitere Farben: siehe Onlineshop 32 GB: Lieferung nur für den gewerblichen Bedarf. Alle Preise zzgl. MwSt.38 | NACHHALTIG


















































BUCHENHOLZNATÜRLICHESAUSDEUTSCHLAND WinkelanzeigeMit Gerade DurchgenieteteAnreisskanteMasstäbe Dauerhafte Federung Lackierte Ausfräsung 39NACHHALTIG | STÜCKAB STÜCKPREIS 1.DRUCKFARBE GRAVURLASER- DIGITAL4C 8003,254003,45-,601,151,452003,75-,651,251,60403,95-,701,301,7014,25 -,55 2.5002,491.5002,95-,50-,90-,991,-1,30 -,45 -,80-,95 Druckkosten weitere Farben: siehe Onlineshop 1 AGDA ZOLLSTOCKQUALITÄTS-2M ab 2 49 1 AGDA 250ERQUALITÄTS-ZOLLSTOCKSERIE, 2 Meter Der Qualitäts-Zollstock verfügt über Präzisionsfedern aus gehärtetem Stahl. Dies sichert eine verschleißfreie und dauerhafte Federung. Das Gelenk mit innenliegenden gehärteten Stahlfedern bleibt immer leichtgängig und exakt bei 90° oder 180° arretierbar. Ohne Freileiste, mit Produkthaftungskennzeichnung und Winkelanzeige in der Innenseite des 1. Gliedes. Made in Germany W Werbedruck. Fläche: 130 x 25 mm Preis/Stk.: ab 40 Stück -,70 Werkzeugkosten: Siehe Serviceseiten. L Lasergravur. Fläche: 130 x 25 mm Preis/Stk.: ab 40 Stück 1,30 Werkzeugkosten: Siehe Serviceseiten. D Digitaldruck 4c. Fläche: 230 x 25 Preis/Stk.:mmab 40 Stück 1,70 Datenhandling: einmalig 29,227 008 natur ab 2,49 100 AGDA 2272ZOLLSTOCKQUALITÄTS-Meter032 479.-WERBETIPP* * Komplettpreis inklusiv einfarbigem, einseitigen Werbeaufdruck in Standardschrift MADE GERMANYIN LANGLEBIGKEIT DURCH PATENTIERTE QUALITÄT






















UMWELTFREUNDLICH SCHLICHT & FUNKTIONAL MADE GERMANYIN NACHHALTIGE KLASSIKER IN NEUEM GEWAND 3 HOLZKUGELSCHREIBER MIT LINEAL FUNKTION Sympathischer Holzkugelschreiber mit 140 mm Skala, blauschreibende Mine W Werbedruck. Fläche: seitlich 60 x 5 mm Preis/Stk.: ab 200 Stück -,16 Werkzeugkosten: Siehe Serviceseiten. L Lasergravur. Fläche: seitlich 100 x 5 mm Preis/Stk.: ab 200 Stück -,35 221 399 ab -,39 STÜCKAB STÜCK-PREIS 1.DRUCKFARBE GRAVURLASER1 -,59 200 -,55 -,16 -,35 500 -,52 -,15 -,30 1.000 -,49 -,14 -,26 2.500 -,46 -,12 -,22 5.000 -,42 -,11 -,20 10.000 -,39 -,10 -,18 Druckkosten weitere Farben: siehe Onlineshop 3 HOLZKUGELSCHREIBER MIT LINEAL FUNKTION ab 0 39 Lieferung nur für den gewerblichen Bedarf. Alle Preise zzgl. MwSt.40 | NACHHALTIG 1 „ARBARO“HOLZKUGELSCHREIBER Druckkugelschreiber aus FSC zertifiziertem Holz aus. Spitze und Klipp aus Metall. Blauschreibende Qualitätsmine. Made in Germany Maße: 14, 5 cm lang W Werbedruck. Fläche: 60 x 7 mm Preis/Stk.: ab 100 Stück -,35 S Siebdruck. Fläche: 60 x 15 mm Preis/Stk.: ab 100 Stück -,35 Werkzeugkosten: siehe Serviceseiten. 213 366 natur ab 1,19 213 374 schwarz ab 1,29 213 382 weiß ab 1,29 STÜCKAB NATURPREIS FARBIGPREIS 1.DRUCKFARBE 1 1,79 1,99 100 1,59 1,79 -,35 250 1,49 1,69 -,30 500 1,39 1,59 -,25 1.0001,29 1,39 -,20 2.5001,19 1,29 -,15 Druckkosten weitere Farben: siehe Onlineshop 1 „ARBARO“HOLZKUGELSCHREIBER ab1 19 2 USB STICK EXPERT 3.0 32 GB Eleganter Plug and Play USB-Stick der 3. Generation mit Bügel aus hochwertigem Stahl, in zwei schöne Holzarten: Ahorn und Walnuss. Hinweis: Die GEMA-Gebühren für USB-Sticks sind in unseren Preisen enthalten und werden abgeführt. Maße: 5,7 x 1,9 x 1 cm W Werbedruck. Fläche: 25 x 10 mm Preis/Stk.: ab 20 Stück 1,80 L Lasergravur. Fläche: 25 x 13 mm Preis/Stk.: ab 20 Stück 2,40 Werkzeugkosten: siehe Serviceseiten. 213 173 Ahorn ab 6,25 213 181 Walnuss ab 6,25 STÜCKAB STÜCKPREIS 1.FARBEDRUCK GRAVURLASER 1 8,95 20 7,95 1,80 2,40 50 7,75 1,60 2,20 1007,45 1,20 1,95 2506,95 -,95 1,45 5006,45 -,65 -,95 1.0006,25 -,34 -,65 Druckkosten weitere Farben: siehe Onlineshop 2 USB STICK EXPERT 3.0 32 GB ab 6 25










































187„COLORADO“BAMBUS-SCHREIBER257 159.-WERBETIPP * Komplettpreis inklusiv einfarbigem, einseitigen Werbeaufdruck in Standardschrift 41NACHHALTIG BAMBUS|TRENDIG UND STILVOLL 1 SCHREIBSET „AMAZONAS“BAMBUS Set aus einem blauschreibenden Druck-Kugelschreiber mit Großraummine, Touchscreen-Spitze und einem Druckbleistift. Schreibgeräte mit Bambusschaft in Papierbox im Bambus-Design. Maße: Ø 1,2 x 14 cm W Werbedruck. Fläche: auf Box: 80 x 20 mm Preis/Stk.: ab 80 Stück -,45 S Siebdruck. Fläche: auf beide Schreiber: ca. 50 x 8 Preis/Stk.:mmab80 Stück -,45/Set Werkzeugkosten: Siehe Serviceseiten. 177 339 ab -,99 1 SCHREIBSETBAMBUS„AMAZONAS“ ab 0 99 SETAB PREISSET- 1.DRUCKFARBE 1 1,69 80 1,59 -,45 200 1,49 -,35 750 1,39 -,30 1.500 1,29 -,25 5.000 -,99 -,22 Druckkosten weitere Farben: siehe Onlineshop 3 „COLORADO“BAMBUS-SCHREIBER Dank seines Schaftes aus Bambus überzeugt dieser Kugelschreiber nicht nur in ökologischer, sondern auch in stilistischer Hinsicht. Mit Metall-Clip und blauschreibender Großraummine. W Werbedruck. Fläche: 50 x 12 mm Preis/Stk.: ab 150 Stück -,28 Werkzeugkosten: Siehe Serviceseiten. 170 482 ab –,49 3 „COLORADO“BAMBUS-SCHREIBER ab 0 49 STÜCKAB STÜCK-PREIS 1.DRUCKFARBE 1 -,65 150 -,60 -,28 250 -,58 -,24 500 -,56 -,21 1.000 -,55 -,18 2.000 -,54 -,16 5.000 -,49 -,14 Druckkosten weitere Farben: siehe Onlineshop 2 „BRENTWOOD“BAMBUSSCHREIBER Dank seines wohlgeformten Korpus erfreut sich dieser blauschreibende Kugelschreiber mit Metall-Clip besonders großer Beliebtheit. Großraummine W Werbedruck. Fläche: 40 x 7 mm Preis/Stk.: ab 100 Stück -,32 Werkzeugkosten: Siehe Serviceseiten. D D igitaldruck 4c. Fläche: 40 x 7 mm Preis/Stk.: ab 100 Stück -,65 Datenhandling: einmalig 29,186 955 ab -,79 STÜCKAB STÜCK-PREIS 1.DRUCKFARBE DIGITAL4C 1 1,19 100 -,99 -,32 -,65 250 -,97 -,26 -,55 500 -,95 -,20 -,50 1.500 -,92 -,18 -,40 3.000-,87 -,15 -,35 5.000-,79 -,12 -,25 Druckkosten weitere Farben: siehe Onlineshop 2 „BRENTWOOD“BAMBUSSCHREIBER ab 0 79DRUCK4C

























SCHREIBER UND ETUIS AUS HOLZ Schönes Etui aus Holz IM2SET Lieferung nur für den gewerblichen Bedarf. Alle Preise zzgl. MwSt.42 | NACHHALTIG 1 HOLZSCHREIBER IM HOLZETUI Dank ihrer Gehäuse aus edlem Naturholz liegen der Kugelschreiber und der Tintenroller – beide blauschreibend – besonders angenehm in der Hand. Besonders schön: auch das Etui ist aus dem gleichen Holz gefertigt. W Werbedruck. Fläche: 100 x 30 mm auf Etui, oder alternativ 30 x 6 mm auf beiden Schreibern Preis/Stk.: ab 15 Stück 2,30 L Lasergravur. Fläche: 30 x 6 mm auf beide Schreiber oder Etui Preis/Stk.: ab 15 Stück 2,95 Werkzeugkosten: siehe Serviceseiten 178 430 ab 5,95 SETAB PREISSET 1.DRUCKFARBE GRAVURLASER1 8,95 15 8,65 2,30 2,95 50 8,25 2,05 2,75 100 7,95 1,95 2,45 250 7,25 1,60 2,25 500 6,95 1,30 1,95 1.000 5,95 -,99 1,45 Druckkosten weitere Farben: siehe Onlineshop 1 IMHOLZ-SCHREIBERHOLZETUI ab5 95 3 HOLZKUGELSCHREIBER IM HOLZETUI Blauschreibender Kugelschreiber mit Großraummine. Auch das Etui ist aus Buchenholz und lässt sich ebenso wie der Kugelschreiber mit einer Gravur besonders schön veredeln. Maße: Etui 17,5 x 2,5 x 2 cm W Werbedruck. Fläche: auf Etui 80 x 15 mm, oder alternativ auf Schreiber 50 x 15 mm Preis/Stk.: ab 50 Stück -,65 L Lasergravur. Fläche: auf Schreiber oder Etui 80 x 7 mm Preis/Stk.: ab 50 Stück 1,15 Werkzeugkosten: Siehe Serviceseiten. 195 466 ab 1,95 STÜCKAB STÜCK-PREIS 1.DRUCKFARBE GRAVURLASER1 3,25 50 2,85 -,65 1,15 150 2,65 -,60 1,05 300 2,45 -,45 -,95 500 2,15 -,35 -,75 1.000 1,95 -,20 -,50 Druckkosten weitere Farben: siehe Onlineshop 3 IMHOLZKUGELSCHREIBERHOLZETUI ab 1 95 2 DRUCKKUGELSCHREIBERBUCHENHOLZ ab 0 99 2 DRUCKKUGELSCHREIBERBUCHENHOLZ Buchenholz-Kugelschreiber mit Klipp und Spitze aus Metall. Blauschreibende auswechselbare Garantiemine. S Siebdruck. Fläche: 40 x 13 mm Preis/Stk.: ab 100 Stück -,32 L Lasergravur. Fläche: 40 x 7 mm Preis/Stk.: ab 100 Stück -,70 Werkzeugkosten: Siehe Serviceseiten. 022 002 ab -,99 STÜCKAB STÜCK-PREIS 1.DRUCKFARBE GRAVURLASER 1 1001,451,55 -,32 -,70 3001,35 -,26 -,60 1.0001,25 -,20 -,50 2.5001,15 -,17 -,30 5.000-,99 -,14 -,25 Druckkosten weitere Farben: siehe Onlineshop 100 123SCHREIBERDRUCKBUCHENHOLZ-KUGEL-084 199.-WERBETIPP*

















































1 MALSET „JULE“ AUS LEINEN Etui aus Leinen und Baumwolle mit sechs Buntstiften sowie Bleistiftanspitzer und Radiergummi. Maße: 19,0 x 19,0 x 0,8 cm SP Spezialsiebdruck Fläche: 130 x 25 Preis/Stk.:mmab 40 Stück -,95 205 220 ab 1,95 STÜCKAB STÜCK-PREIS 1.DRUCKFARBE 1 3,60 40 3,15 -,95 1002,95 -,75 250 2,55 -,65 5002,25 -,50 1.000 1,95 -,35 Druckkosten weitere Farben: siehe Onlineshop 1 MALSET „JULE“ ab 1 95 2 BAMBUS LINEAL 30 cm Für messbare und vor allem nachhaltige Werbeerfolge! Das Lineal aus dem nachwachsenden Rohstoff Bambus bietet eine perfekte Werbefläche auf 30 cm. Maße: 30,9 x 3,2 x 0,3 cm W Werbedruck. Fläche: 150 x 15 mm Preis/Stk.: ab 150 Stück -,28 213 190 ab -,59 STÜCKAB STÜCKPREIS 1.DRUCKFARBE 1 150-,89-,99 -,28 300 -,85 -,24 700-,79 -,20 1.500-,69 -,15 2.500-,59 -,10 Druckkosten weitere Farben: siehe Onlineshop 2 BAMBUS LINEAL 30 cm ab0 59 3 MITBAMBUS-ORGANIZERINDUKTIVERLADESTATION Ein besonderer Blickfang auf dem Schreibtisch. Organizer mit induktiver Ladestation aus Bambus und ABS. Kompatibel mit allen QI-fähigen Geräten. Inkl. 80 cm USB-Ladekabel. Ausgang DC 5 V / 1.0 A. Maße: 27 x 14,5 x 1,5 cm W Werbedruck. Fläche: 100 x 20 mm Preis/Stk.: ab 8 Stück 3,50 Werkzeugkosten: Siehe Serviceseiten. 214 406 ab 13,95 STÜCKAB STÜCKPREIS 1.DRUCKFARBE 1 18,95 8 17,95 3,50 15 16,95 2,50 30 15,95 1,80 50 14,95 1,40 150 14,25 1,10 300 13,95 -,80 Druckkosten weitere Farben: siehe Onlineshop 3 LADESTATIONMITBAMBUS-ORGANIZERINDUKTIVER ab 13 95 * Komplettpreis inklusiv einfarbigem, einseitigen Werbeaufdruck in Standardschrift FÜRWERBEERFOLGENACHHALTIGE 43NACHHALTIG |




























































DRUCK4C UP 1 SPIELKARTEN AUS RECYCELTEM PAPIER ab 0 69 1 SPIELKARTEN AUS RECYCELTEM PAPIER Nachhaltig ist Ass. Spielkarten aus recyceltem Papier in einer Schachtel aus recyceltem Karton. 54 Karten (4x13 und 2 Joker). W Werbedruck. Fläche: auf die Box 60 x 20 mm Preis/Stk.: ab 120 Stück -,35 221 402 ab -,69 STÜCKAB STÜCK-PREIS 1.DRUCKFARBE 1 -,95 120 -,90 -,35 300 -,85 -,30 600 -,80 -,25 1.200 -,75 -,22 2.500 -,69 -,18 Druckkosten weitere Farben: siehe Onlineshop Lieferung nur für den gewerblichen Bedarf. Alle Preise zzgl. MwSt.44 | NACHHALTIG 3 PAPYRUS KUGELSCHREIBERRECYCLINGPAPIERLeichter Kugelschreiber aus RecyclingPapier mit farblich abgestimmter Kappe, blauschreibend. W Fläche:Werbedruck. 60 x 6 mm auf Schaft Preis/Stk.: ab 400 Stück -,16 Werkzeugkosten: Siehe Serviceseiten. D Digitaldruck 4c. Fläche: 60 x 4 mm auf Schaft Preis/Stk.: ab 400 Stück -,39 Datenhandling: einmalig 29,206 242 weiß ab -,18 206 259 natur ab -,18 206 267 rot ab -,18 206 275 blau ab -,18 206 283 grün ab -,18 206 291 schwarz ab -,18 STÜCKAB STÜCK-PREIS 1.DRUCKFARBE DIGITAL4C 4001-,32-,27 -,16-,39 800-,26 -,15 -,36 2.000 -,24 -,14-,32 4.000-,22 -,13 -,28 10.000 -,20 -,10-,25 20.000-,18 -,09-,20 Druckkosten weitere Farben: siehe Onlineshop 3 KUGELSCHREIBERRECYCLINGPAPIER-PAPYRUS ab 0 18 2 SCHREIBER AUS RECYCLING PAPIER ab 0 14 2 SCHREIBER AUS RECYCLING PAPIER Umweltbewusst, zuverlässig, günstig: schwarzschreibender Kugelschreiber mit einem Schaft aus Recyclingpapier. S Siebdruck. Fläche: auf Schaft 50 x 7 mm Preis/Stk.: ab 500 Stück -,15 180 313 blau ab -,14 180 321 grün ab -,14 180 330 rot ab -,14 180 348 schwarz ab -,14 STÜCKAB STÜCK-PREIS 1.DRUCKFARBE 1 -,25 500 -,22 -,15 1000 -,19 -,14 2.000 -,17 -,13 4.000 -,16 -,10 10.000 -,14 -,09 Druckkosten weitere Farben: siehe Onlineshop






































































STÜCK12 2 BLEISTIFTENATURHOLZab1 49 2 MITNATURHOLZ-BLEISTIFTRADIERGUMMI 1 Set / 12 Stk. Bleistifte aus naturbelassenem Holz. Mit weißem Radiergummi in goldfarbener Metallöse. Einzelkarton. Maße: 18,2 cm lang S Siebdruck. Fläche: 50 x 20 mm Preis/Set: ab 70 Sets 1,75 Werkzeugkosten: Siehe Serviceseiten. 011 797 1,49 SETAB PREISSET- 1.DRUCKFARBE 701,8911,99 1,75 1501,79 1,45 3001,69 1,25 5001,49 1,15 Druckkosten weitere Farben: siehe Onlineshop STÜCKAB STÜCK-PREIS 1.DRUCKFARBE 1 10,95 10 10,45 2,50 50 9,95 1,70 100 9,75 1,40 200 8,95 1,10 500 7,95 -,80 Druckkosten weitere Farben: siehe Onlineshop Wechsellichtfunktion 3 WIRELESSBAMBUS SPEAKER ab7 95 1 KORK KUGELSCHREIBER Eine Oberfläche aus natürlichem Kork verleiht diesem blauschreibenden Kugelschreiber aus Kunststoff eine einzigartige Haptik. Man möchte ihn gar nicht mehr aus der Hand legen. Setzen auch Sie ein besonderes Statement, indem Sie ihn durch Ihr Logo veredeln. W Werbedruck. Fläche: 30 x 6 mm auf dem Klipp Preis/Stk.: ab 250 Stück Werkzeugkosten: Siehe Serviceseiten. 190 438 ab -,29 STÜCKAB STÜCK-PREIS 1.DRUCKFARBE 1 -,46 250 -,42 -,20 500 -,40 -,19 1.500 -,38 -,18 5.000-,35 -,16 10.000 -,29 -,14 Druckkosten weitere Farben: siehe Onlineshop -,20 1 KUGELSCHREIBERKORK ab 0 29 45NACHHALTIG | 3 BAMBUS WIRELESS SPEAKER Hightech im kabellose BluetoothLautsprecher aus ABS-Kunststoff mit Bambus-Gehäuse. Wechsellichtfunktion (verschiedene Farben) oben und unten am Gehäuse, aufladbarer Lithium-Ionen-Akku (300mAh), Micro-USB-Kabel. 3 Watt, Akkulaufzeit: ca. 3 h. Maße: Ø 7,2 x 4,5 cm W Werbedruck. Fläche: 30 x 15 mm Preis/Stk: ab 10 Stück 2,50 Werkzeugkosten: Siehe Serviceseiten. 197 476 ab 7,95














USE Lieferung nur für den gewerblichen Bedarf. Alle Preise zzgl. MwSt.46 | NACHHALTIG Nachdem der Bleistift aufgebraucht ist, drücken Sie den Sprout bis zum oberen Rand der Samenkapsel in die Erde. Wasser, Sonne und Liebe nicht vergessen! 1 SPROUT BLEISTIFT MIT SAMENKAPSEL ab 1 65 1 SPROUT BLEISTIFT MIT SAMENKAPSEL Der erste Bleistift der wächst, sobald er zum Schreiben zu kurz ist. Jeder Stift enthält eine biologisch abbaubare Samenkapsel. Wird der Stumpf eingepflanzt und regelmäßig gegossen, entwickelt sich daraus ein wunderschönes Pflänzchen. Natürlich sind auch die Sprout Stifte selbst bleifrei, biologisch abbaubar und aus nachhaltig gewonnenen Materialien hergestellt. L Lasergravur. Fläche: 100 x 5 mm Preis/Stk.: ab 50 Stück -,80 Werkzeugkosten: Siehe Serviceseiten. 201 556 Basilikum ab 1,65 201 564 Vergissmeinnicht ab 1,65 201 572 Sonnenblume ab 1,65 220 646 Thymian ab 1,65 220 654 Gänseblümchen ab 1,65 STÜCKAB STÜCK-PREIS GRAVURLASER1 2,85 50 2,55 -,80 100 2,35 -,70 2502,15 -,60 500 1,95 -,50 1.5001,65 -,35 ZWEITES LEBEN
Der weltweit erste Bleistift, den man einpflanzen und daraus Kräuter oder Blumen züchten kann. Anstatt den Stift wegzuwerfen, können Sie ihn einpflanzen und beim Wachsen zusehen. Die Sprout Stifte sind 100% nachhaltig. Sie sind aus zertifiziertem FSC-Lindenholz hergestellt und bestehen aus biologisch abbaubaren und natürlichen Materialien.




































Unterseite aus Edelstahl MADE GERMANYIN 1 BUNTSTIFTSPROUT ab 1 65 1 SPROUT BUNTSTIFT Ein Buntstift, der wächst! Der Sprout ist der weltweit einzige originale und patentierte Stift mit Samenkapsel. Nachdem dieser seine Dienste zum Schreiben geleistet hat, kommt der Buntstift-Stummel nicht wie üblich in den Müll, sondern in den Blumentopf! L Lasergravur. Fläche: 100 x 5 mm Preis/Stk.: ab 50 Stück -,80 Werkzeugkosten: Siehe Serviceseiten. 220 620 Basilikum ab 1,65 220 638 Vergissmeinicht ab 1,65 STÜCKAB STÜCK-PREIS GRAVURLASER1 2,85 USE 3 BOOJITO FLASCHENÖFFNER Robuster und zugleich eleganter Edelstahl-Flaschenöffner mit angenehmem Bambusmantel. Maße: 17, 8 × 4 × 1 cm W Werbedruck. Fläche: Oberseite 70 x 20 mm Preis/Stk.: ab 50 Stück -,70 L Lasergravur. Fläche: Oberseite 70 x 20 mm Preis/Stk.: ab 50 Stück 1,Werkzeugkosten: Siehe Serviceseiten. 220 316 ab 1,65 STÜCKAB STÜCK-PREIS WERBE-DRUCK GRAVURLASER5012,952,65 -,701,100 2,55 -,60 -,85 250 2,45 -,50-,75 500 2,25 -,40-,65 1.000 1,95 -,30-,50 5.000 1,65 -,15-,30 Druckkosten weitere Farben: siehe Onlineshop 3 FLASCHENÖFFNERBOOJITO ab 1 65 50 2,55 -,80 100 2,35 -,70 250 2,15 -,60 500 1,95 -,50 1.500 1,65 -,35 2 GRILLZANGE ECO GRIP Umweltfreundliche und vielseitig einsetzbare Zange aus Buchenholz. Made in Europe W Werbedruck. Fläche: seitlich 80 x 13 mm Preis/Stk.: ab 100 Stück -,40 L Lasergravur. Fläche: seitlich 80 x 13 mm Preis/Stk.: ab 100 Stück -,90 Werkzeugkosten: Siehe Serviceseiten. 221 454 ab -,79 2 GRILLZANGE ECO GRIP ab 0 79 STÜCKAB STÜCK-PREIS 1.DRUCKFARBE GRAVURLASER10011,251,15 -,40-,90 250 1,05 -,35-,80 500 -,95 -,30-,70 1.000 -,90 -,25-,50 2.500 -,85 5.000-,79-,15-,30-,20-,40 Druckkosten weitere Farben: siehe Onlineshop 47NACHHALTIG |



































































Die innovative Kunststoffhülle des blauschreibenden Kugelschreibers besteht zu 30 % aus Kaffeesatz. Ebenso nachhaltig ist der Clip mit einem Weizenstrohanteil von 30 %. Mit Ihrem Logo auf dem Clip lassen Sie keinen Zweifel daran, dass Ihre Marke hinter diesem nachhaltigen Giveaway steht. W Werbedruck. Fläche: auf Klipp 40 x 7 mm Preis/Stk.: ab 200 Stück -,20 Werkzeugkosten: Siehe Serviceseiten. 215 752 braun ab -,45 215 769 natur ab -,45 215 777 hellgrün ab -,45
1 HISPAR RPET KUGELSCHREIBER
Siehe Serviceseiten. D Digitaldruck 4c. Fläche: seitlich 60 x 60 mm Preis/Stk.: ab 7 Stück 6,50 Datenhandling: einmalig 29,Maße: 8,5 x 10 x 9 cm 215 701 ab 11,95 STÜCKAB STÜCKPREIS 1.DRUCKFARBE 1 -,67 200 -,61 -,20 500 -,59 -,19 1.000 -,57 -,17 2.500 -,54 -,15 5.000 -,49 -,13 10.000 -,45 -,12 Druckkosten weitere Farben: siehe Onlineshop 1 HISPAR KUGELSCHREIBERRPET ab 0 29 2 KAFFEE SCHREIBER ab 0 45 3 STIFTEKÖCHERMULTIFUNKTIONALERDOWEX ab 11 95 STÜCKAB STÜCK-PREIS 1.DRUCKFARBE 1 -,55 250 -,42 -,18 500 -,40 -,16 1.000 -,38 -,14 2.500 -,36 -,12 5.000 -,34 -,10 10.000 -,29 -,09 Druckkosten weitere Farben: siehe Onlineshop STÜCKAB STÜCK-PREIS 1.DRUCKFARBE DIGITAL4C 7117,9516,95 4,506,50 15 15,95 3,95 5,95 50 14,95 2,954,95 100 13,95 1,953,95 200 12,95 1,452,45 300 11,95 -,951,95 Druckkosten weitere Farben: siehe Onlineshop
2 KAFFEE SCHREIBER
ZUKUNFTSWEISENDE MATERIALIEN TEP DRUCK4C Lieferung nur für den gewerblichen Bedarf. Alle Preise zzgl. MwSt.48 | NACHHALTIG
Nachhaltige Werbeerfolge garantiert dieser transparente Kugelschreiber aus recyceltem PET Polyester (RPET). Mit Druckmechanismus, blauschreibend. S Siebdruck. Fläche: seitl. 60 x 12 mm Preis/Stk.: ab 250 Stück -,18 Werkzeugkosten: Siehe Serviceseiten. 215 710 blau ab -,29 215 728 rot ab -,29 215 736 transparent ab -,29 215 744 grün ab -,29
Ein Stifteköcher, der längst nicht nur Stiften den perfekten Platz auf dem Schreibtisch bietet. Dank integrierter Handy-Halterung, Wireless-Charger (max. Ausgang: 1000mA) und 3-PortUSB-Hub (USB 2.0) versorgt der Stifteköcher aus nachhaltigem WeizenstrohKunststoff auch Smartphone & Co. mit Power. Inkl. USB-Ladekabel. W Werbedruck. Fläche: seitlich 55 x 55 mm Preis/Stk.: ab 7 Stück 4,50 Werkzeugkosten:
3 DOWEX STIFTEKÖCHERMULTIFUNKTIONALER













































2 INDUKTIVE LADESTATION AUS WEIZENSTROH Ein zukunftsweisendes Trendprodukt, das die fossilen Ressourcen unseres Planeten schont! Der Kunststoff dieser kabellosen Ladestation wurde anteilig durch nachwachsenden Weizenstroh ersetzt. Das Gerät verfügt über eine 5-Watt-Ladespule und ist mit Kurzschluss-, Überspannungs- und Überhitzungsschutz ausgestattet. Inkl. 1-Meter-Ladekabel, um den Charger mit Strom zu versorgen. Maße: 9 x 9 x 0,9 cm W Werbedruck. Fläche: 60 x 30 mm Preis/Stk.: ab 10 Stück 1,50 Werkzeugkosten: Siehe Serviceseiten. oder D Digitaldruck 4c. Fläche: 90 x 90 Preis/Stk.:mmab 10 Stück 2,95 Datenhandling: einmalig 29,204 833 ab 6,99 DRUCKDRUCK4C4C STÜCKAB STÜCK-PREIS 1.DRUCKFARBE DIGITAL4C 1019,959,25 1,502,95 308,95 1,20 2,50 50 8,75 -,901,95 1808,25 -,75 1,45 200 7,45 -,601,25 5006,99 -,50 -,95 Druckkosten weitere Farben: siehe Onlineshop 2 LADESTATIONINDUKTIVE AUS WEIZENSTROH ab 6 99 3 METMAXX WEIZENSTROHLADESTATIONChargeGreenAUS ab 4 25DRUCK4C 49NACHHALTIG | 1 WEIZENSTROH SCHREIBER Kugelschreiber aus Recycling-Papier mit Teilen aus Weizenstroh-Kunststoff und verchromten Elementen, blauschreibend. W Fläche:Werbedruck. 40 x 7 mm auf Schaft Preis/Stk.: ab 400 Stück -,16 Werkzeugkosten: Siehe Serviceseiten. D Digitaldruck 4c. Fläche: 40 x7 mm auf Schaft Preis/Stk.: ab 400 Stück -,32 Datenhandling: einmalig 29,211 143 weiß ab -,18 211 151 blau ab -,18 211 160 rot ab -,18 211 178 orange ab -,18 211 186 grün ab -,18 STÜCKAB STÜCK-PREIS 1.DRUCKFARBE DIGITAL4C 4001-,33-,28 -,16-,32 800-,27 -,15 -,28 1.500 -,24 -,13-,26 2.500-,22 -,12 -,24 5.000 -,20 -,11-,20 10.000-,18 -,10-,18 Druckkosten weitere Farben: siehe Onlineshop 1 SCHREIBERWEIZENSTROH ab 0 18 3 METMAXX WEIZENSTROHLADESTATIONChargeGreenAUS Dieses fast charging wireless Ladegerät im Öko Dress aus Weizenstrohkunststoff findet überall Platz. Inkl. 1 Meter Kabel, Micro-USB Port, fast charging mit bis zu 10 Watt. Maße: Ø 10,1 x 7 cm W Werbedruck. Fläche: Ø 60 mm Preis/Stk.: ab 25 Stück 1,30 Werkzeugkosten: Siehe Serviceseiten. D Digitaldruck 4c. Fläche: Ø 60 mm Preis/Stk.: ab 25 Stück 3,25 Datenhandling: einmalig 29,214 359 ab 4,25 STÜCKAB STÜCKPREIS 1.DRUCKFARBE DIGITAL4C 256,4516,65 1,30 2501005,951,102,75506,251,202,953,25 5,45 2.5004,251.0004,95-,651,255005,25-,801,95-,902,25 -,45 -,95 Druckkosten weitere Farben: siehe Onlineshop






































TEP AUF DIE NACHHALTIGKEIT KOMMT ES AN hergestellt aus recycelten PET-Flaschen 1 AUSKUGELSCHREIBERRECYCELTEMPET Klassischer Kugelschreiber aus recyceltem PET, transparent mit silbernen Applikationen, Gummimanschette und blau schreibender Großraummine. W Werbedruck. Fläche: seitlich 40 x 7 mm Preis/Stk.: ab 400 Stück -,17 Werkzeugkosten: Siehe Serviceseiten. 220 381 blau ab -,19 220 390 weiß ab -,19 2 KUGELSCHREIBER AUS RECYCELTEM PAPIER Umweltfreundlich und gleichzeitig günstig. Blauschreibender Kugelschreiber aus recyceltem Papier. Die farbigen Applikationen sind aus Mais gefertigt. W Werbedruck. Fläche: seitlich 60 x 6 mm Preis/Stk.: ab 500 Stück -,15 Werkzeugkosten: Siehe Serviceseiten. 220 404 blau ab -,16 220 412 grün ab -,16 220 429 natur ab -,16 220 437 rot ab -,16 220 445 schwarz ab -,16 STÜCKAB STÜCKPREIS 1.DRUCKFARBE 1 -,26 500 -,23 -,15 1.000 -,21 -,14 2.000 -,19 -,13 4.000 -,18 -,12 10.000 -,16 -,11 Druckkosten weitere Farben: siehe Onlineshop 1 AUSKUGELSCHREIBERRECYCELTEM PET ab 0 19 2 KUGELSCHREIBER AUS RECYCELTEM PAPIER ab 0 16 STÜCKAB STÜCK-PREIS 1.DRUCKFARBE 1 -,35 400 -,32 -,17 1.000 -,29 -,14 2.500 -,26 -,13 5.000 -,23 -,11 10.000 -,19 -,09 Druckkosten weitere Farben: siehe Onlineshop 3 BAMBUS KUGELSCHREIBER Kugelschreiber aus Bambus mit Kunststoffspitze und Metallclip. Schwarze Mine. S Siebdruck. Fläche: seitlich 50 x 12 mm Preis/Stk.: ab 150 Stück -,25 Werkzeugkosten: Siehe Serviceseiten. 220 373 ab -,49 STÜCKAB STÜCK-PREIS 1.DRUCKFARBE 1 -,69 150 -,62 -,25 250 -,59 -,23 500 -,58 -,20 1.000 -,56 -,18 2.000 -,54 -,16 5.000 -,49 -,14 Druckkosten weitere Farben: siehe Onlineshop 3 BAMBUS KUGELSCHREIBER ab 0 49 Lieferung nur für den gewerblichen Bedarf. Alle Preise zzgl. MwSt.50 | NACHHALTIG























































1 WERBESET „ÖKO“ 225 TEILE Legen Sie Wert auf nachhaltige Werbung! In diesem Set enthalten sind 150 Haftnotizblöcke, 70 Bambusschreiber sowie 5 Holzpowerbanks. Im Preis inbegriffen ist ein einseitiger, einfarbiger Werbedruck sowie die Grundkosten für Standardschrift. Bei Logo/Sonderschrift zzgl. 13,187 097 239,-
225TEILE239 .TouchscreenBedienhilfe 2 MITBAMBUS-SCHREIBERTOUCH ab 0 29
Kugelschreiber mit Druckmechanismus, schicken Bambusschaft und Touchscreen-Bedienhilfe an der Spitze ausgestattet – für kapazitive TouchscreenOberflächen wie Tablet-PCs geeignet – blauschreibende Großraummine Maße: Ø 1,2 x 14 cm W Werbedruck. Fläche: 50 x 13 mm auf Schaft Preis/Stk.: ab 250 Stück -,17 L Lasergravur. Fläche: 80 x 7 mm auf Schaft Preis/Stk.: ab 250 Stück -,30 Werkzeugkosten: Siehe Serviceseiten. 206 996 ab -,29 STÜCKAB STÜCK-PREIS 1.DRUCKFARBE GRAVURLASER2501-,59-,52 -,17 -,30 500-,47 -,16 -,28 1.000 -,44 -,15 -,25 2.500-,39 -,13 -,23 5.000 -,34 -,12-,18 10.000-,29 -,09 -,15 Druckkosten weitere Farben: siehe Onlineshop
2 MITBAMBUS-SCHREIBERTOUCH
51NACHHALTIG | NACHHALTIG GUT & DAUERHAFT





































































































Lieferung nur für den gewerblichen Bedarf. Alle Preise zzgl. MwSt.52 | PRÄSENTIERTHOCHWERTIGNACHHALTIGDURCH KORK 1 FEDERMAPPE KORK Kork vereint nur die besten Eigenschaften: pflegeleicht, reißfest und vor allem nachhaltig! So wie diese Federmappe mit Reißverschluss für Stifte, Radiergummis & Co. Maße: 23 x 11 cm W Werbedruck. Fläche: 100 x 30 mm Preis/Stk.: ab 50 Stück -,70 Werkzeugkosten: Siehe Serviceseiten. 194 504 ab 1,45 STÜCKAB STÜCK-PREIS 1.DRUCKFARBE 1 2,85 50 2,40 -,70 2002,15 -,65 500 1,95 -,55 1.0001,75 -,40 2.000 1,45 -,35 Druckkosten weitere Farben: siehe Onlineshop 1 FEDERMAPPEKORK ab 1 45 2 „ROTTERDAMSCHREIBER ECO“ ab 0 22 2 SCHREIBER „ROTTERDAM ECO“ Ganz im Sinne der Umwelt: Der Schaft dieses Kugelschreibers ist aus Kork und für Spitze, Klipp und Drücker kommen nur recycelte Materialen zum Einsatz. Mit blauschreibender X-22 Mine. W Werbedruck. Fläche: 60 x 6 mm seitlich vom Klipp 25 x 3 mm auf dem Klipp Preis/Stk.: ab 400 Stück -,16 Werkzeugkosten: Siehe Serviceseiten. 198 022 natur ab -,22 197 999 rot ab -,22 198 006 grün ab -,22 198 014 weiß ab -,22 STÜCKAB STÜCK-PREIS 1.DRUCKFARBE 1 -,36 400 -,32 -,16 1.000-,30 -,15 2.500 -,28 -,14 5.000-,26 -,13 10.000 -,22 -,11 Druckkosten weitere Farben: siehe Onlineshop
































Hier ist zusammen, zusammengehört:
In den Untersetzer aus natürlichem Kork ist ein Flaschenöffner integriert. Maße: 10 x 10 cm W Werbedruck. Fläche: 50 x 25 mm Preis/Stk.: ab 50 Stück -,80 L Lasergravur. Fläche: 50 x 25 mm Preis/Stk.: ab 50 Stück 1,60 Werkzeugkosten: Siehe Serviceseiten. 194 473 ab 1,95 STÜCKAB STÜCK-PREIS 1.DRUCKFARBE GRAVURLASER5012,952,85 -,801,60 100 2,65 -,701,40 250 2,35 -,601,20 500 2,05 -,50-,90 1.000 1,95 -,40-,80 Druckkosten weitere Farben: siehe Onlineshop 2 UNTERSETZER KORK MIT FLASCHENÖFFNER ab 1 95 1 KORK PALAISEAU-RECHTECKSCHLÜSSELANHÄNGER Werbemittel aus natürlichen Materialien sind im Trend und versprechen nachhaltige Erfolge. So wie dieser Schlüsselanhänger aus Kork, der Ihr Unternehmenslogo bestens in Szene setzt. Maße: 7 x 3,5 x 0,3 cm W Werbedruck. Fläche: 40 x 18 mm Preis/Stk.: ab 70 Stück -,55 L Lasergravur. Fläche: 40 x 18 mm Preis/Stk.: ab 70 Stück -,75 Werkzeugkosten: Siehe Serviceseiten. 191 471 ab 1,29 STÜCKAB STÜCK-PREIS 1.DRUCKFARBE GRAVURLASER7012,091,99 -,55 -,75 150 1,89 -,50-,70 500 1,69 -,45 -,65 1.000 1,49 -,35 -,55 2.500 1,39 -,30-,50 5.000 1,29 -,25 -,45 Druckkosten weitere Farben: siehe Onlineshop 1 KORK PALAISEAU-RECHTECKANHÄNGERSCHLÜSSELab 1 29
was
3 KORK SCHREIBSET
Ein edles Schreibset ist immer eine ganz besondere Aufmerksamkeit und setzt Ihr Firmenlogo langlebig in Szene. Dieses Set besticht durch seine Oberflächen aus natürlichem Kork – sowohl auf dem Etui als auch auf Drehkugelschreiber und Tintenroller aus Edelstahl. Maße: Etui 18 x 5,6 x 3 cm W Werbedruck. Fläche: auf das Etui 80 x 25 mm, oder auf beide Schreiber 40 x 5 mm Preis/Stk: ab 12 Stück 2,90 Werkzeugkosten: Siehe Serviceseiten. 196 651 ab STÜCKAB STÜCK-PREIS
SCHON GEWUSST?
1.DRUCKFARBE 1 10,95 12 9,95 2,90 30 9,65 2,50 100 8,95 2,20 200 8,45 1,95 400 7,95 1,50 Druckkosten weitere Farben: siehe Onlineshop 3 KORK SCHREIBSET ab 7 95 53NACHHALTIG | 2 UNTERSETZER KORK MIT FLASCHENÖFFNER
Das Material Kork als eine nachhaltige Alternative, die dabei hilft, Plastikmüll in der Umwelt zu vermeiden.
7,95
Korkeichen sind sehr wichtig für das Ökosystem. Da man die wertvollen Bäume nicht abholzt, sondern nur erntet, kommt dieses nicht ins Ungleichgewicht.







































3 HOLZ-ZETTELBOX ab 2 95 2 HOLZ JOJO Das Jojo in klassischem Design ist aus echtem Naturholz gefertigt. Maße: Ø 5 x 2,8 cm W Werbedruck. Fläche: 30 x 20 Preis/Stk.:mmab 250 Stück -,19 L Lasergravur. Fläche: 30 x 20 mm Preis/Stk.: ab 250 Stück -,35 195 659 ab -,29 STÜCKAB STÜCK-PREIS 1.DRUCKFARBE GRAVURLASER 2501-,59-,50 -,19-,35 500 -,45 -,18-,30 1.500 -,40 -,16-,25 2.500 -,35 -,15-,20 5.000 -,29 -,14-,18 Druckkosten weitere Farben: siehe Onlineshop 2 HOLZ JOJO ab 0 29 1 „NATURE“NOTIZBUCH ab 0 59 ORGANIC UMWELTFREUNDLICHE ALTERNATIVEN FÜR IHR BÜRO Lieferung nur für den gewerblichen Bedarf. Alle Preise zzgl. MwSt.54 | NACHHALTIG STÜCKAB STÜCK-PREIS 1.DRUCKFARBE 1 150-,89-,95 -,30 500 -,85 -,28 1.000-,79 -,26 2.500-,69 -,24 5.000-,59 -,22 Druckkosten weitere Farben: siehe Onlineshop 3 HOLZ-ZETTELBOX Auf dem unbehandelten Kiefernholz kommt Ihre Werbebotschaft besonders gut zur Geltung. Maße: 10 x 10 x 8,5 cm W Werbedruck. Fläche: 60 x 50 mm Preis/Stk.: ab 108 Stück -,45 L Lasergravur. Fläche: 60 x 30 mm Preis/Stk.: ab 108 Stück 2,175 261 ohne Druck ab 2,95 176 287 mit Druck ab 2,95 STÜCKAB STÜCK-PREIS 1.DRUCKFARBE GRAVURLASER10814,954,45-,45 2.0162,95-,25-,701.0083,65-,30-,905043,85-,351,402524,15-,401,802,Druckkosten weitere Farben: siehe Onlineshop 1 NOTIZBUCH „NATURE“ Aus Recycling-Papier und -Pappe mit Druckkugelschreiber, dessen Schaft ebenfalls aus recycelter Pappe ist, Drücker, Klipp und Spitze sind aus Recycling-Kunststoff. Maße: ca. 11,1 x 8,4 x 0,8 cm W Werbedruck. Fläche: 50 x 20 mm Preis/Stk.: ab 150 Stück -,30 116 905 natur/blau ab -,59 116 913 natur/schw. ab -,59 116 921 natur/rot ab -,59 116 930 natur/grün ab -,59
















































































DESIGNKLASSIKER IN ÖKOLOGISCHEM GEWAND Derzuliebe!Umwelt 55NACHHALTIG | 1 A5 NOTIZBUCH AUS RECYCELTEM PAPIER A5 Notizbuch mit Umschlag aus recyceltem Karton, Lesezeichen, 160 gepunkteten Seiten aus Recyclingpapier und Gummibandverschluss. Werbedruckauf dem Einband. Maße: 14 x 21 x 1 cm W Werbedruck. Fläche: 80 x 50 mm Preis/Stk.: ab 50 Stück -,65 P Prägung. Fläche: 80 x 50 mm Preis/Stk.: ab 50 Stück -,75 Werkzeugkosten: Siehe Serviceseiten. 210 732 natur ab 1,65 210 749 schwarz ab 1,65 210 757 rot ab 1,65 210 765 grau ab 1,65 210 773 grün ab 1,65 2 A4 KLEMMBRETT/ ORGANIZER Klassisches Klemmbrett aus nachhaltigem Karton mit stabiler Klammer um Dokumente zu sichern und ausziehbarer Öse zum Aufhängen. Ihre Werbung wird auf das Klemmbrett gedruckt. Maße: 24 x 35 cm W Werbedruck. Fläche: 130 x 50 Preis/Stk.:mmab 80 Stück -,40 Werkzeugkosten: Siehe Serviceseiten. 210 781 ab -,95 STÜCKAB STÜCK-PREIS 1.DRUCKFARBE PRÄGUNG 5012,752,55 -,65-,75 100 2,40 -,60 -,70 200 2,20 -,55 -,65 500 1,95 -,50-,60 1.000 1,75 -,40 -,55 2.000 1,65 -,30 -,45 Druckkosten weitere Farben: siehe Onlineshop STÜCKAB STÜCK-PREIS 1.DRUCKFARBE 1 1,69 80 1,55 -,40 150 1,45 -,35 300 1,35 -,30 600 1,25 -,25 1.500 1,10 -,20 3.000 -,95 -,15 Druckkosten weitere Farben: siehe Onlineshop 1 A5 NOTIZBUCH AUS RECYCELTEM PAPIER ab 1 65 2 A4 ORGANIZERKLEMMBRETT/ ab 0 95



















































































































































































EIN GENUSS VEGAN | ÖKOLOGISCH | NATÜRLICH 1 ESSBAREKULERO LÖFFEL 3 65IM10SET IM10SET 3 KNUSPERHALME 3 45 1 KULERO ESSBARE LÖFFEL 10 Löffel, 110 g Löffel für Löffel die Umwelt schützen! Mit ihren biologisch abbaubaren Löffeln hat Kulero auch schon in der Höhle der Löwen für Furore gesorgt. Nach Gebrauch können die knusprigen, veganen Löffel, die zu 100 % aus natürlichen Zutaten bestehen, ganz einfach aufgegessen werden. Dennoch bleiben sie 60 Minuten in kalten und 30 Minuten in heißen Speisen stabil. Maße: 7 x 4,5 x 16 cm 213 229 Kakao 3,65 213 237 Klassik 3,65 213 245 Masala 3,65 3 KNUSPERHALME 10 Trinkhalme Mit diesen Knusperhalmen können Sie nicht nur auf umweltschädliche Plastikhalme verzichten, sondern zugleich für ein zusätzliches Knabber-Highlight in Ihren Getränken sorgen. Die veganen Halme bestehen aus Hartweizengrieß, Wasser und Rapsöl. Sie bleiben etwa 60 Minuten in kalten Getränken stabil und sind auch für warme Getränke geeignet. Maße: 4 x 3 x 27 cm 213 253 3,45 2 KULERO 3ER PROBIERSET 3er Set , 29 g Löffel für Löffel die Umwelt schützen! Dieses Probier-Set mit den Varianten Klassik, Kakao und Masala ist perfekt für alle, die sich einen ersten Eindruck von den essbaren Löffeln sowie den drei Geschmacksrichtungen von Kulero machen möchten. Maße: Verpackung 7 x 4,5 x 16 cm 213 212 1,95 2 3ERKULEROPROBIERSET 1 95IM3SET VEGANVEGAN VEGAN Lieferung nur für den gewerblichen Bedarf. Alle Preise zzgl. MwSt.56 | NACHHALTIG

































































USE Orange-Kurkuma Kakao-Kirsche 1 BIO SNACK ENERGY BALLS 24 g, 2 Stück Diese Snack Bällchen sorgen für Stimmung mit jedem Bissen. HAPPY (Orange-Kurkuma) stabilisiert die Psyche mit Rhodiolaextrakt, während RELAX (Kakao-Kirsche) dank Ashwagandha vom stressigen Büroalltag entspannt. Beide Sorten enthalten den Tagesbedarf an natürlichem Vitamin B12. Inhalt: 24 g Merkmale: Öko Prüfziffer DE-Öko-006 221 366 Orange-KurkumaHAPPY 1,99 221 374 Kakao-KirscheRELAX 1,99 2 BIO GOOD MOOD COOKIE KAKAO UND HANF 50 g Der GOOD MOOD Cookie für gute Laune. Sättigt langanhaltend mit Ashwagandha und Reishi Vitalpilz Extrakt und 7g Protein! Die gesunde Alternative zu Süßigkeiten Inhalt: 50 g Merkmale: Öko Prüfziffer DE-Öko-006 221 382 1,99 3 BONBONDOSE FRESH METALL INKL. NOSTALGIE BONBONS 135 g Eine runde Sache: Werben Sie mit der klimaneutralen Bonbondose, gefüllt mit vielen leckeren Bonbons Made in Germany. Die praktische Werbedose besteht aus 98 % recycelbarem Weißblech und einem individuell bedruckbarem Stülpdeckel aus Metall. Die edle Dose und die leckere FruchtbonbonFüllung helfen Ihre Werbebotschaft zu verbreiten und gleichzeitig der Umwelt Gutes zu tun. Inhalt: 135 g W Werbedruck. Fläche: auf die Box Ø 80 mm Preis/Stk.: ab 30 Stück 1,20 D Digitaldruck. Fläche: Auf den Deckel Ø 80 mm Preis/Stk.: ab 30 Stück 2,20 Datenhandling: einmalig 29,223 486 ab 2,95 STÜCKAB STÜCK-PREIS 1.DRUCKFARBE DIGITAL4C 3014,253,95 1,20 2,20 100 3,75 -,80 1,60 200 3,45 -,60 1,20 500 3,25 -,40 -,95 1.000 2,95 -,30 -,60 Druckkosten weitere Farben: siehe Onlineshop DRUCK4C 1 BIO SNACK ENERGY BALLS 1 99 2 BIO GOOD MOOD COOKIE KAKAO UND HANF 1 99 3 FRESHBONBONDOSEMETALL ab 2 95 GERMANYMADEINHALTIN VEGANVEGAN 57NACHHALTIG |






















































































































RPET = ÖKO LOGISCH! UP TEP TEP USE Lieferung nur für den gewerblichen Bedarf. Alle Preise zzgl. MwSt.58 | NACHHALTIG 1 RPET LANYARD 20 mm Mit diesen Schlüsselbändern setzen Sie nicht nur Ihre Werbebotschaft bestens in Szene, sondern zeigen zugleich, dass Ihnen die Umwelt am Herzen liegt. Die Schlüsselbänder sind aus zu 100 % recycelten PETGetränkeflaschen gefertigt und damit ressourcenschonend und nachhaltig. Maße: 45 x 2 cm SP Spezialsiebdruck. Fläche: 200 x 12 Preis/Stk.:mmab 150 Stück -,45 Werkzeugkosten: Siehe Serviceseiten. 210 441 schwarz ab -,45 210 450 rot ab -,45 210 468 weiß ab -,45 210 476 royalblau ab -,45 2 RPET TRINKFLASCHE 500 ml Diese Trinkfl aschen sind ein tolles Beispiel dafür, wie man durch Recycling von PET-Flaschen ein neues, langlebiges Produkt schaffen kann. Mit Drehverschluss aus Metall und praktischer Trageschlaufe. Maße: Ø 7 x 16 cm W Werbedruck. Fläche: 30 x 40 mm Preis/Stk.: ab 40 Stück -,80 Werkzeugkosten: Siehe Serviceseiten. 210 685 blau ab 1,99 210 693 rot ab 1,99 210 708 weiß ab 1,99 1 RPET LANYARD ab 0 45 2 RPET FLASCHETRINKab 1 99 STÜCKAB STÜCK-PREIS 1.DRUCKFARBE 1 -,75 150 -,70 -,45 300 -,65 -,40 1.000 -,60 -,35 2.500 -,55 -,30 5.000 -,45 -,28 Druckkosten weitere Farben: siehe Onlineshop STÜCKAB STÜCK-PREIS 1.DRUCKFARBE 1 3,65 40 3,50 -,80 80 3,25 -,75 150 3,05 -,70 300 2,75 -,60 600 2,45 -,50 1.500 2,25 -,40 3.000 1,99 -,30 Druckkosten weitere Farben: siehe Onlineshop























































ExtralangeHenkel 38 x cm42 59NACHHALTIG | 2 BAUMWOLLTASCHE MIT LANGEN HENKELN aus Fairtrade zertifizierter Baumwolle Diese klassische Stofftasche aus 100 % Fairtrade zertifi zierte Baumwolle lässt sich dank der 70 cm langen Henkel ganz bequem über der Schulter tragen. Eingeschla gene und umsäumte Innennähte sorgen für Stabilität und unterstreichen die hochwertige Verarbeitung. Material : 100% Fairtrade-zertifi zierter Baumwolle, zertifi ziert nach OEKO-TEX Standard 100 Gewicht : ca. 140 g/m² Lizenzen / Zertifi kate: Fairtrade, OEKO-TEX Maße: 38 x 42 cm SP Spezialsiebdruck. Fläche: 280 x 280 mm Preis/Stk.: ab 80 Stück -,48 Werkzeugkosten: Siehe Serviceseiten. 205 107 natur ab 1,49 205 115 blau ab 1,89 205 123 schwarz ab 1,89 205 131 rot ab 1,89 205 140 grün ab 1,89 STÜCKAB STK.-PREISNATUR STK.-PREISFARBIG 1.DRUCKFARBE FARBEWEIT. 1 2,292,69 80 2,19 2,49 -,48-,25 1502,092,45 -,40 -,24 300 1,99 2,39 -,37-,23 1.0001,752,09 -,35-,22 2.500 1,651,95 -,32-,18 5.0001,491,89 -,31 -,16 2 HENKELNMITBAUMWOLLTASCHELANGEN ab 1 49 1 BAUMWOLLTASCHE, KURZE HENKEL aus Fairtrade-zertifizierter Baumwolle Zeigen Sie, dass Ihnen die Umwelt am Herzen liegt! Material : 100% Fairtrade-zertifi zierter Baumwolle, zertifi ziert nach OEKO-TEX Standard 100 Gewicht : ca. 140 g/m² Lizenzen / Zertifi kate: Fairtrade, OEKO-TEX Maße: 38 x 42 cm SP Spezialsiebdruck. Fläche: 280 x280 Preis/Stk.:mmab 80 Stück -,42 Werkzeugkosten: Siehe Serviceseiten. 195 763 natur ab 1,29 195 771 blau ab 1,69 195 780 schwarz ab 1,69 195 798 rot ab 1,69 195 802 grün ab 1,69 STÜCKAB STK.-PREISNATUR STK.-PREISFARBIG 1.DRUCKFARBE WEITEREFARBE 1 2,192,49 80 1,99 2,29 -,42-,25 150 1,95 2,19 -,37-,24 300 1,85 2,09 -,36-,23 1.000 1,651,95 -,34-,22 2.500 1,491,79 -,32-,18 5.000 1,291,69 -,31-,16 1 BAUMWOLLTASCHE ab 1 29
















































UP Lieferung nur für den gewerblichen Bedarf. Alle Preise zzgl. MwSt.60 | UNTERWEGSWERBETRÄGERRESSOURCENSCHONENDENACHHALTIGFÜR 1 BAUMWOLLEAUSTASCHE/RUCKSACKRECYCELTER Pluspunkt für die Umwelt! Für diese Taschen kommen nur in der Textilproduktion anfallende Stoffreste zum Einsatz, welche nach Farben sortiert, zerkleinert und zu neuen Garnen versponnen werden. Das Ergebnis kann sich sehen lassen: Die Kordeltaschen können zugleich als Rucksack getragen werden und bieten perfekte Werbemöglichkeiten. Maß e: ca. 37 x 40 cm Material: ca. 140 g/m2 SP Spezialsiebdruck. Fläche: 240 x 200 mm Preis/Stk.: ab 30 Stück 1,25 Werkzeugkosten: Siehe Serviceseiten. 195 819 natur ab 2,65 195 827 rosé ab 2,65 195 835 blau ab 2,65 195 843 dunkelblau ab 2,65 195 851 grau ab 2,65 1 BAUMWOLLEAUSTASCHE/RUCKSACKRECYCELTER ab 2 65 STÜCKAB STÜCK-PREIS 1.DRUCKFARBE 3013,753,45 1,25 1003,25 1,15 250 2,95 -,99 5002,75 -,95 1.000 2,65 -,85 Druckkosten weitere Farben: siehe Onlineshop 2 JUTETASCHE „KALKUT“ Natürlicher Look mit farbigem Akzent. Grober Jutestoff und ein bunter Tragegriff aus Baumwollstoff machen diese Tasche zu einem praktischen Einkaufsbegleiter. Maße: 38 x 40 cm SP Spezialsiebdruck. Fläche: 280 x 280 mm Preis/Stk.: ab 40 Stück -,99 Werkzeugkosten: Siehe Serviceseiten. 188 792 blau ab 1,95 188 805 beige ab 1,95 188 813 orange ab 1,95 188 821 grün ab 1,95 188 830 schwarz ab 1,95 STÜCKAB STÜCK-PREIS 1.DRUCKFARBE 1 3,35 40 3,15 -,99 100 3,05 -,89 250 2,90 -,85 500 2,65 -,75 1.000 2,35 -,65 2.500 1,95 -,60 Druckkosten weitere Farben: siehe Onlineshop 2 „KALKUT“JUTETASCHE ab 1 95













































































ERLEBENTRENDSERLEBENKLASSIKERNEUENEUE UP 61NACHHALTIG | 1 BAUMWOLL NETZTASCHE Ein Klassiker, der als Trendaccessoire sein Comeback feiert! Neu ist die großzügige Fläche, die Ihre Werbebotschaft perfekt in Szene setzt. Die naturfarbene Tasche ist aus 100 % Baumwolle nach OEKO-TEX Standard 100 und hat zwei lange Tragegriffe. Materialgewicht : 190 g/m2 Maße: ca. 35 x 41 cm SP Spezialsiebdruck. Fläche: 180 x 55 Preis/Stk.:mmab 30 Stück 1,50 Werkzeugkosten: Siehe Serviceseiten. 210 343 ab 2,49 2 RECYCELTE BAUMWOLLTASCHE 140g/m2 Oeko-Tex® STANDARD 100 zertifizierte, recycelte Baumwolltasche mit langen Tragehenkeln und einer Grammatur von 140g/m². Die Werbung wird auf eine Seite der Tasche gedruckt. Maße: 38 x 42 cm SP Spezialsiebdruck. Fläche: 280 x 280 mm Preis/Stk.: ab 100 Stück -,60 Werkzeugkosten: Siehe Serviceseiten. 210 644 anthrazit ab -,89 210 652 blau ab -,89 210 669 rot ab -,89 210 677 natur ab -,89 1 NETZTASCHEBAUMWOLL ab 2 49 2 BAUMWOLLTASCHERECYCELTE ab 0 89 STÜCKAB STÜCK-PREIS 1.DRUCKFARBE 1 3,85 30 3,75 1,50 60 3,50 1,20 150 3,25 -,80 250 3,15 -,60 500 2,75 -,50 1.000 2,49 -,40 Druckkosten weitere Farben: siehe Onlineshop STÜCKAB STÜCK-PREIS 1.DRUCKFARBE 1 1,29 100 1,19 -,60 200 1,15 -,55 500 1,10 -,50 1.500 -,99 -,45 3.000 -,89 -,35 Druckkosten weitere Farben: siehe Onlineshop














































SO GEHT EINKAUFEN ROBUST, LEICHT WIEDERVERWENDBAR& Mit Henkel 37 x 55 cm Medium 26 x 35 cm 3 BIO & „EVA“FOODFAIRBAG ab 0 99 3 BIO & „ADAM“FOODFAIRBAG ab 1 09 Mit Zugkorkel USE UP TEP Large 30 x 40 cm DRUCK4C Lieferung nur für den gewerblichen Bedarf. Alle Preise zzgl. MwSt.62 | NACHHALTIG 1 OBSTMIT„ECOCARE“GEMÜSEBEUTELUNDHENKEL ab 0 99 1 OBSTMEDIUM„ECOCARE“GEMÜSEBEUTELUND ab 0 69 1 OBSTLARGE„ECOCARE“GEMÜSEBEUTELUND ab 0 79 2 BIO & FAIR FOOD BAG So einfach lässt sich Plastikmüll reduzieren! Die langlebigen und waschbaren Beutel sind ideal für den Einkauf von Obst, Gemüse und Backwaren. Ihr Eigengewicht ist bereits deklariert und kann bequem an der Kasse abgezogen werden. Aus 84% Biobaumwolle und 16% rPET-Mesh. Mit Fairtrade- und GOTS-Zertifizierung. FLO ID 39624 Lizenzen / Zertifi kate: Fairtrade, OEKO-TEX Maße: 25 x 30 cm Eva, 30 x 40 cm Adam SP Spezialsiebdruck. Fläche: 150 x 120 mm (Eva) bzw. 250 x 210 mm (Adam) Preis/Stk.: ab 80 Stück -,55 Werkzeugkosten: Siehe Serviceseiten. 191 916 Eva ab -,99 191 924 Adam ab 1,09 1 OBST- UND EINKAUFSTASCHEGEMÜSEBEUTEL„ECOCARE“ Wiederverwendbarer Kunststoffbeutel statt Plastiktüte! Die Beutel aus 100% Polyester sind nicht nur leicht und stabil, sondern auch bei 30 Grad waschbar und immer wieder verwendbar. Maße: 37 x 58 cm mit Henkel, 26 x 35 cm medium, 30 x 40 cm large SU Sublimationsdruck 4C. Fläche: 250 x 150 mm (mit Henkel) bzw. 160 x 130 mm (medium) 210 x 140 mm (large) Preis/Stk.: ab 80 Stück -,85 Werkzeugkosten: Siehe Serviceseiten. 200 506 mit Henkel ab -,99 200 514 medium ab -,69 200 522 large ab -,79 STÜCKAB STK-PREISADAM STK-PREISEVA 1.DRUCKFARBE 8011,851,651,701,55 -,55 1501,601,45 -,50 300 1,501,35 -,40 6001,401,25 -,35 1.000 1,20 1,15 -,30 5.0001,09-,99 -,20 Druckkosten weitere Farben: siehe Onlineshop STÜCKAB STK-PREISMEDIUM STK-PREISLARGE DRUCK4C 8011,151,351,051,20 -,65 1501,-1,09 -,55 500 -,90-,99 -,50 1.500-,80-,89 -,45 2.500 -,69 -,79-,35 STÜCKAB STÜCKPREISMITHENKEL DRUCK4C 1 1,95 80 1,79 -,85 1501,69 -,80 500 1,49 -,75 1.5001,29 -,65 2.500 -,99 -,55








































































SCHON GEWUSST? Baumwolle gehört zu den ältesten Nutzpflanzen der Welt. Baumwollpflanzen wurden an verschiedenen Orten rund um die Welt unabhängig voneinander angebaut. Die ältesten Hinweise auf Baumwollverarbeitung stammen aus Indien und reichen bis in das Jahr 6000 v.Chr. zurück. 63NACHHALTIG | 1 BaumwolleausTURNBEUTELFairtrade-zertifizierter Turnbeutel mit robusten Zugbändern auch praktisch als Rucksack tragbar. Die Kordeln sind bei allen Farbvarianten naturfarben. Die saubere Verarbeitung mit versäumten Innennähten setzt Ihre Werbebotschaft gekonnt in Szene. Material : 100% Fairtrade-zertifizierter Baumwolle, zertifi ziert nach OEKO-TEX Standard 100 Gewicht : ca. 140 g/m² Lizenzen / Zertifi kate: Fairtrade, OEKO-TEX Maße: 38 x 46 cm SP Spezialsiebdruck. Fläche: 220 x 200 mm Preis/Stk.: ab 40 Stück -,95 Werkzeugkosten: Siehe Serviceseiten. 213 307 natur ab 2,19 213 261 maigrün ab 2,89 213 270 gelb ab 2,89 213 288 mandarin ab 2,89 213 296 pink ab 2,89 213 315 stahlgrau ab 2,89 213 323 royalblau ab 2,89 213 331 rot ab 2,89 213 340 schwarz ab 2,89 STÜCKAB NATURPREIS FARBIGPREIS 1.DRUCKFARBE 13,55 4,45–40 3,25 4,05 -,95 100 3,053,65 -,85 250 2,85 3,45 -,75 500 2,55 3,25 -,70 1.000 2,35 3,15 -,65 2.000 2,19 2,89 -,55 Druckkosten weitere Farben: siehe Onlineshop 1 TURNBEUTEL ab 2 19





















































RPET
SCHON
UP
1 TASCHE WEISS Tasche aus 100% recycelten PET-Flaschen, absolut ökologisch, langlebig und sehr robust, jeweils mit kurzem oder langem Henkel. Materialgewicht ca. 120g/m2 Maße: 38 x 42 cm SP Spezialsiebdruck. Fläche: 250 x 180 mm Preis/Stk.: ab 70 Stück -,75 Werkzeugkosten: Siehe Serviceseiten. D Digitaldruck 4C. Fläche: 250 x 180 mm Preis/Stk.: ab 70 Stück
UP TEP GEWUSST? So entstehen unsere RPET-Werbeträger: es werden leere, gereinigte PET-Flaschen zerkleinert, zu Granulat und anschließend zu Folien verarbeitet. Daraus entsteht Ihr neuer Werbeträger, der nach mehrmaligen Einsatz ebenfalls wieder recycelt werden kann, um daraus wieder neue, andere Kunststoff-Produkte herzustellen. TEP
Lieferung nur für den gewerblichen Bedarf. Alle Preise zzgl. MwSt.64 | NACHHALTIG
1,85 Datenhandling: einmalig 29,210 351 kurzer Henkel ab 1,29 210 360 langer Henkel ab 1,39 2 RPET EINKAUFSTASCHE Absolut ökologisch! Was eben noch PET-Flaschen waren, sind nun robuste und langlebige Tragetaschen mit langem Henkel. Maße: 38 x 42 cm SP Spezialsiebdruck. Fläche: 240 x 200 mm Preis/Stk.: ab 100 Stück -,42 Werkzeugkosten: Siehe Serviceseiten. 210 378 schwarz ab -,85 210 386 rot ab -,85 210 394 weiß ab -,85 210 409 orange ab -,85 210 417 royalblau ab -,85 1 RPET TASCHE WEISS KURZER HENKEL ab 1 29 1 RPET TASCHE WEISS LANGER HENKEL ab 1 39 2 RPET EINKAUFSTASCHE ab 0 85 STÜCKAB KURZERHENKEL LANGERHENKEL 1.DRUCKFARBE DIGITAL4C 7012,152,352,052,25 -,751,85 150 1,95 2,15 -,701,75 300 1,85 2,05 -,651,45 500 1,751,85 -,601,20 1.000 1,551,59 -,50-,90 2.500 1,291,39 -,40-,80 Druckkosten weitere Farben: siehe Onlineshop STÜCKAB STÜCK-PREIS 1.DRUCKFARBE 1 1,55 100 1,45 -,42 200 1,35 -,40 500 1,05 -,38 1.000 -,95 -,34 2.500 -,85 -,32 Druckkosten weitere Farben: siehe Onlineshop DRUCK4C
















































































TEP schwarz grau OCEANPLASTIC 1 WURFSCHEIBE 22 cm WEISS 100% OCEAN-PLASTIC ab 1 59 DRUCK4C Aus PLA 65NACHHALTIG | 2 HETUI WINTERMÜTZE AUS RPET Dieser warmen Wintermütze sieht man ihr Vorleben nicht an: Das fein gestrickte Material wird aus gebrauchten und recycelten PET-Flaschen hergestellt, sogenanntes RPET-Polyester (300 g/ m²). Ob in Grau, Schwarz oder Dunkelblau – alle Mützen können auch mit Einzelnamen personalisiert werden. ST Stickerei. Fläche: Vorne 100 x 30 mm Preis/Stk.: ab 25 Stück 3,25 Werkzeugkosten: Siehe Serviceseiten. 215 849 schwarz ab 2,95 215 857 dunkelblau ab 2,95 215 865 grau ab 2,95 Einzelnamen:215873schwarz 10,95 215 881 dunkelblau 10,95 215 890 grau 10,95 STÜCKAB STÜCKPREIS STICKEREI 1 5,65 25 5,15 3,25 50 4,95 2,99 100 4,65 2,70 250 3,95 2,50 500 3,25 1,99 1.000 2,95 1,70 Druckkosten weitere Farben: siehe Onlineshop 2 HETUI WINTERMÜTZE AUS RPET ab 2 95 dunkelblau 1 WURFSCHEIBE 22 cm WEISS 100% OCEAN-PLASTIC Jährlich landen Tonnen von Einwegplastik in den Ozeanen. Lösungen werden dringend benötigt! Das für diese Wurfscheibe verwendete Ocean-Plastic wird aus Kunststoffabfällen, die aus dem Meer gefischt sowie am Strand gesammelt und wieder aufbereitet wurden, hergestellt. 100% recycelbar. Made in Germany. Maße: Ø 22 x 3 cm W Werbedruck. Fläche: Ø 100 mm Preis/Stk.: ab 50 Stück -,75 Werkzeugkosten: siehe Serviceseiten. D Digitaldruck 4c. Fläche: Ø 135 mm Preis/Stk.: ab 50 Stück 1,70 Datenhandling: einmalig 29,213 358 ab 1,59 STÜCKAB STÜCKPREIS 1.DRUCKFARBE DIGITAL4C 502,1912,39 -,75 1,70 1002,09 -,55 5001,79-,352501,99-,40-,901,30 -,85 2.0001,59-,25-,601.0001,69-,30-,75 Druckkosten weitere Farben: siehe Onlineshop PHTHAL AT FREE PHTHA L AT FREE 3 REGENPONCHO AUS PLA kompostierbar Gut für die Umwelt - Phthalatfreier, transparenter Regenponcho aus PLA mit Tragetasche zum Transportieren. Dieser Poncho ist kompostierbar und somit eine nachhaltige Einwegalternative. Maße: Tasche 15 x 12 x 1 cm 210 636 1,39 3 AUSREGENPONCHOPLA 1 39













































































Mit diesem Taschenschirm setzen Sie auch bei schlechtem Wetter äußerst positive und vor allem nachhaltige Akzente. Bei diesem Schirm sind sowohl der Bezugsstoff (STANDARD 100 by OEKO-TEX® Polyester-Pongee) als auch der Griff aus recycelten Kunststoffen. Das Gestell bietet dank bewährtem Windproof-System auch bei stärkeren Windböen maximale Gestell-Flexibilität. Einen wichtigen Beitrag zur Vermeidung von Plastikmüll geht Fare mit dem Futteral, welches als praktische Einkaufstasche mit Staufach für den Schirm genutzt werden kann. Maße:Ø 98 cm SP Fläche:Spezialsiebdruck. 220 x 200 mm auf die Tasche, oder 220 x 100 mm auf Schirm-Segment Preis/Stk.:
STURMSICHERWINDPROOF-SYSTEM Im Handumdrehen 2 ÖKOBRELLAMINIFARE®-STYLETASCHENSCHIRMSHOPPING ab 9 95 IN21 2 FARE®-STYLE MINI TASCHENSCHIRM ÖKOBRELLA SHOPPING
ab 12 Stück 2,95 Werkzeugkosten: Siehe Serviceseiten. 201 513 limette ab 9,95 201 521 marine ab 9,95 201 530 grau ab 9,95 201 548 schwarz ab 9,95 STÜCKAB STÜCK-PREIS DRUCK 1. FARBE AUF TASCHE DRUCK 1. FARBE AUF SCHIRM 12113,9512,95 2,95 2,95 48 11,95 2,50 2,50 120 11,45 2,20 2,20 24010,95 1,85 1,85 480 9,95 1,65 1,65 Druckkosten weitere Farben: siehe Onlineshop UP Standard 100 by Öko-Tex Windproof-systemSTURMSICHER Echtholzgriffund-Spitzen 1 FARE®-AC STOCKSCHIRM „ÖKOBRELLA“ Dieser nachhaltige Stockschirm mit Bezug aus recycelten Kunststoffen und Echtholzelementen setzt Akzente. Die komfortable Automatik-Funktion zum schnellen Öffnen, die Windproof-Features für höhere Gestell-Flexibilität und die bessere Windsicherheit mit flexiblen Fiberglasschienen sind weitere Highlights. STANDARD 100 by OEKO-TEX® zertifiziertes Polyester-Pongee Bezugsmaterial aus recycelten Kunststoffen. Die schwarze Galvanisierung des Stahlstocks erhöht den Korrosionsschutz. Maße: Ø 105 cm SP Spezialsiebdruck. Fläche: 210 x 120 mm auf ein Schirm-Segment Preis/Segment.: ab 12 Stück 1,85 Werkzeugkosten: Siehe Serviceseiten. 205 916 marine ab 8,95 205 908 limette ab 8,95 205 924 schwarz ab 8,95 STÜCKAB STÜCK-PREIS 1.DRUCKFARBE 1 12,95 12 11,50 1,85 40 10,45 1,65 100 9,95 1,45 300 9,45 1,35 600 8,95 -,99 Druckkosten weitere Farben: siehe Onlineshop 1 „ÖKOBRELLA“STOCKSCHIRMFARE®-AC ab 8 95 UP Lieferung nur für den gewerblichen Bedarf. Alle Preise zzgl. MwSt.66 | NACHHALTIG






























































































REGENSCHIRM AUS RE PET-FLASCHENCYCELTEN FÜR EINE BESSERE WELT 1 STOCKSCHIRM
TEP UP 67NACHHALTIG |
bietet auf seiner Bespannung aus RPET-Pongee (190T) eine tolle Werbefläche. Maße: 83,2 x Ø 104 cm SP Fläche:Spezialsiebdruck. auf Segment 200 x 100 mm Preis/Stk.: ab 20 Stück 1,85 Werkzeugkosten: Siehe Serviceseiten. 205 238 schwarz ab 3,95 205 246 blau ab 3,95 205 254 grün ab 3,95 205 262 rot ab 3,95 STÜCKAB STÜCK-PREIS 1.DRUCKFARBE 1 7,15 20 6,65 1,85 50 6,35 1,70 100 5,85 1,50 2505,35 1,30 500 4,95 1,20 1.0003,95 -,95 Druckkosten weitere Farben: siehe Onlineshop 1 „JOHN“STOCKSCHIRMRPET ab 3 95
Diese Regenschirme sind zu 100% nachhaltig! Aus zerkleinerten Plastikflaschen wird ein neues Material gewonnen: RPET, woraus die Bespannung dieser Regenschirme hergestellt wird. Alle RPET-Produkte leisten einen positiven Beitrag zum Umweltschutz, da bei der Verarbeitung von RPET 90% weniger Wasser benötigt ist und 70% weniger CO2 ausgestoßen wird als bei der Herstellung von herkömmlichen Kunststoff. Täglich werden Millionen Plastikflaschen weggeworfen. 80% der Kosten einer Wasserflasche sind die Produktionskosten der Flasche. Recycling ist deshalb auch wirtschaftlich klug. „JOHN“ Gezieltes Marketing auch an Schlechtwettertagen. Dieser Automatik-Regenschirm mit Bambusgriff und Metallgestell
RPET























recycelbarVON
DER ROHSTOFFEN.WACHSENDENAUSPRODUKTERECYCELBAREZULIEBE.100%UMWELT1NACHROHSTOFFEN.WACHSENDEN
Der Schutz der Umwelt ist das wichtigste gesellschaftliche Thema unserer Zeit. Darum setzen wir verstärkt auf nachhaltige Kunststoffe. Für das BIO-Produktsortiment auf dieser Doppelseite kommen sogenannte biobasierte „drop-in“ Kunststoffe zum Einsatz. Diese werden statt aus Erdöl aus nachwachsenden Rohstoffen – in unserem Fall Zuckerrohr – hergestellt. Weitere Pluspunkte: Sämtliche Produkte aus Biokunststoff sind „Made in Germany“, somit entfallen lange Transportwege. Sie sind zu 100 % recycelbar und sogar spülmaschinengeeignet.
1 ALLE TRINKFLASCHEN, BROTDOSEN & CO. SIND FREI SCHADSTOFFEN, PHTHALATEN SOWIE BPA. GETESTET NACH EU-NORM 10/2011.
1 „FITNESS“BIO-TRINKFLASCHE ab 1 59 MADE GERMANYIN USE Lieferung nur für den gewerblichen Bedarf. Alle Preise zzgl. MwSt.68 | NACHHALTIG 1 BIO-TRINKFLASCHE „FITNESS“ 500 ml Der ideale Begleiter für Fitness & Sport! Durch ihren Push-Pull-VerschlussverriegelbarensinddieBioTrinkflaschen absolut auslaufsicher. Maße: Ø 7,5 x 18,5 cm W Werbedruck. Fläche: 25 x 15 mm Preis/Stk.: ab 50 Stück -,85 Werkzeugkosten: Siehe Serviceseiten. 195 361 grün ab 1,59 195 370 blau ab 1,59 195 388 rot ab 1,59 STÜCKAB STÜCK-PREIS 1.DRUCKFARBE 1 2,65 50 2,35 -,85 100 2,20 -,65 500 1,95 -,50 1.000 1,75 -,40 3.000 1,59 -,25 Druckkosten weitere Farben: siehe Onlineshop



























SCHON GEWUSST? Jährlich landen allein in Deutschland fast drei Milliarden Pappbecher im Müll. Darum setzen wir auf diese nachhaltige Alternative: Dieser langlebige To-go-Becher besteht aus mindestens 84 % des nachwachsenden Rohstoffs Zuckerrohr und kann zu 100 % recycelt werden. DRUCK4C MADE GERMANYIN USEFREE MADE GERMANYIN USEFREE USEFREE 69NACHHALTIG | 1 „WELTKUGEL“BIO-SNACKBOX ab 1 59 1 BIO-SNACKBOX „WELTKUGEL“ Die runden Snackboxen im attraktiven Weltkugeldesign sind perfekt für die Mitnahme von frischem Obst, Gemüse und kleinen Leckereien. Und das ganz ohne schlechtes Gewissen. Maße: 16 x 12 x 6 cm W Werbedruck. Fläche: 30 x 12 mm Preis/Stk.: ab 50 Stück -,75 Werkzeugkosten: Siehe Serviceseiten. 195 440 blau ab 1,59 195 458 grün ab 1,59 STÜCKAB STÜCK-PREIS 1.DRUCKFARBE 1 2,85 50 2,55 -,75 150 2,35 -,65 500 1,95 -,55 1.000 1,75 -,45 3.000 1,59 -,40 Druckkosten weitere Farben: siehe Onlineshop 2 BIO-COFFEE-TO-GO BECHER 350 ml An eine hohe Benutzerfreundlichkeit wurde auch gedacht: Für einen sicheren Transport der Getränke sorgt ein Stülpdeckel mit Verschlussklappe. Maße: 14 x Ø 8,5 cm W Werbedruck. Fläche: 25 x 15 mm Preis/Stk.: ab 25 Stück 1,45 Werkzeugkosten: Siehe Serviceseiten. 195 396 grün ab 2,85 195 407 blau ab 2,85 195 415 rot ab 2,85 STÜCKAB STÜCK-PREIS 1.DRUCKFARBE 1 4,75 25 4,35 1,45 50 4,15 1,25 100 3,95 -,95 250 3,45 -,65 500 3,25 -,45 1.000 2,85 -,35 Druckkosten weitere Farben: siehe Onlineshop 2 BECHERBIO-COFFEE-TO-GO ab 2 85 3 BIO-SNACKBOX Genießen Sie Ihre Snacks und Pausenbrote ganz im Sinne der Umwelt: Maße: 18 x 13 x 7 cm W Werbedruck. Fläche: 70 x 40 mm Preis/Stk.: ab 50 Stück -,75 Werkzeugkosten: Siehe Serviceseiten. D Digitaldruck 4c. Fläche: 120 x 80 Preis/Stk.:mmab 50 Stück 1,45 Datenhandling: einmalig 29,195 423 grün ab 1,59 195 431 weiß ab 1,59 STÜCKAB STÜCK-PREIS 1.DRUCKFARBE DIGITAL4C 1 2,85 50 2,55 -,75 1,45 150 2,35 -,55 1,15 500 1,95 -,50 1,1.500 1,75 -,45 -,90 3.000 1,59 -,40 -,75 Druckkosten weitere Farben: siehe Onlineshop 3 BIO-SNACKBOX ab 1 59






















































































1 KOZIOL EIERBOX „EGGS TO GO“ „EGGS TO GO“ ist perfekt zum Einkaufen auf dem Markt oder im nächsten Hofladen. Sie transportiert bis zu 10 Eier sicher nach Hause und spart dazu jede Menge Einwegverpackungen. Die Dose hat einen praktischen Clipverschluss zum einfachen Öffnen und Schließen. Und das stoßfeste Material verhindert zuverlässig, dass die Eier beschädigt
oder zerdrückt werden. Im Kühlschrank können die Boxen problemlos gestapelt werden, so bleibt mehr Stauraum für weitere Lebensmittel. Maße: 11,8 x 27,7 x 7,3 cm W Werbedruck. Fläche: 120 x 70 mm Preis/Stk.: ab 20 Stück 1,85 Werkzeugkosten: Siehe Serviceseiten. D Digitaldruck 4c. Fläche: 200 x 70 Preis/Stk.:mmab 20 Stück 4,35 Datenhandling: einmalig 29,214 641 organic green ab 3,95 214 650 organic grey ab 3,95 STÜCKAB STÜCKPREIS 1.DRUCKFARBE DIGITAL4C Druckkosten5003,95-,701,552504,951,-2,651005,251,303,10505,451,553,85205,751,854,3515,95–weitereFarben:sieheOnlineshop USE ORGANIC
SCHON GEWUSST? Koziol setzt aus Überzeugung ausschließlich auf thermoplastische Kunststoffe, die zu 100% recycelbar sind. Thermoplaste sind die umweltfreundlichsten Materialien, die es auf dem Markt gibt. Sie sind lebensmittelecht, spülmaschinenfest und sie kommen bei der Verarbeitung ohne jegliche Zusätze wie Formaldehyd oder Weichmacher (BPA) aus. DRUCK4C ORGANIC USE Lieferung nur für den gewerblichen Bedarf. Alle Preise zzgl. MwSt.70 | NACHHALTIG 2 LUNCHBOXKOZIOL „BASIC“ ab 1 95 2 KOZIOL LUNCHBOX „BASIC“ Praktischer Begleiter für Schule, Büro und Ausflüge. Denn ob Brote, Snacks oder Obst – in der geräumigen Lunchbox mit Clipverschluss bleibt alles frisch und knackig. Spülmaschinengeeignet und selbstverständlich frei von BPA und Melamin. Maße: 6,6 x 16,8 x 12,2 cm W Werbedruck. Fläche: 100 x 50 mm oben Preis/Stk: ab 40 Stück -,95 Werkzeugkosten: Siehe Serviceseiten. D Digitaldruck 4c. Fläche: 120 x 60 mm oben Preis/Stk.: ab 40 Stück 2,15 Datenhandling: einmalig 29,200 651 cotton white ab 1,95 200 660 organic green ab 1,95 200 678 organic grey ab 1,95 200 686 organic pink ab 1,95 STÜCKAB STÜCK-PREIS 1.DRUCKFARBE DIGITAL4C Druckkosten1.5008004001504013,15–2,99-,952,152,89-,851,952,59-,751,752,39-,651,501,95-,45-,99weitereFarben:sieheOnlineshop 1 KOZIOL EIERBOX „EGGS TO GO“ ab 3 95DRUCK4C





























































Mit verschlussSchraubMADE GERMANYIN MADE GERMANYIN ORGANIC USE ORGANIC USE ORGANIC USE 71NACHHALTIG | 1 „PLOPPTRINKFLASCHEKOZIOLTOGO“ ab 6 95 3 KOZIOL „PASCAL“LUNCHBOX-SET 6teilig, inkl. Besteck Bei dieser geräumigen Lunchbox mit Clipverschluss finden Obst, Salate u.v.m. im geräumigen Inneren Platz und können in den zwei integrierten kleinen Boxen verstaut werden, die auch separat genutzt werden können. Messer, Gabel, Löffel können besonders platzsparend ineinandergesteckt werden. Natürlich sind alle Bestandteile spülmaschinengeeignet. Maße: Box L: 23,2 x 16,6 x 6,2 cm; Box M: 9,6 x 7 x 5,2 cm; Box S: 15,1 x 10,8 x 6 cm; Besteckset: 22,2 x 4,8 x 3,6 cm W Werbedruck. Fläche: Auf alle 3 Teile in Einheitsgröße 45 x 60 mm Preis/Set: ab 8 Sets 4,95 Werkzeugkosten: Siehe Serviceseiten. 196 555 organic green ab 10,95 196 583 organic grey ab 10,95 1 KOZIOL TRINKFLASCHE „PLOPP TO GO“ Trinkflasche mit dem kultigen PloppVerschluss aus Keramik! Ganz im Sinne der Zero-Waste-Bewegung ist diese Trinkflasche toll für unterwegs und kann immer wieder nachgefüllt werden, so dass weniger Einwegflaschen benötigt werden. Ein weiterer Vorteil: Die zweiteilige Trinkflasche kann komplett zerlegt und damit besonders gründlich in der Spülmaschine gereinigt werden. Maße: 7,4 x 7,4 x 25,3 cm W Werbedruck. Fläche: 15 x 40 mm Preis/Stk: ab 12 Stück 1,90 Werkzeugkosten: Siehe Serviceseiten. 196 571 organic green ab 6,95 196 580 organic grey ab 6,95 3 KOZIOL LUNCHBOX SET „PASCAL“ ab 10 95 SETAB PREISSET- 1.DRUCKFARBE 1 16,95 8 15,95 4,95 15 15,45 4,65 50 14,45 3,95 100 13,95 2,95 200 12,95 1,95 500 10,95 1,50 Druckkosten weitere Farben: siehe Onlineshop 2 KOZIOL THERMOBECHER MIT DECKEL „AROMA TO GO“ 400 ml Dieser Thermobecher begleitet Sie mit einem Lächeln und hält dabei Ihre Heißgetränke in perfekter Trinktemperatur! Dank flexibler Lamellen sitzt der Deckel besonders sicher auf dem für die Spülmaschine geeigneten Becher, die Manschette schmeichelt den Händen und bietet einen optimalen Hitzeschutz. Maße: 9,2 x 9,2 x 12 cm W Werbedruck. Fläche: 20 x 15 mm Preis/Stk: ab 20 Stück 1,80 Werkzeugkosten: Siehe Serviceseiten. 196 598 organic green ab 4,95 196 602 organic grey ab 4,95 2 KOZIOL THERMOBECHER MIT DECKEL „AROMA TO GO“ ab 4 95 STÜCKAB STÜCK-PREIS 1.DRUCKFARBE 1 10,95 12 9,95 1,90 30 9,75 1,80 60 9,55 1,50 100 8,95 1,10 300 7,95 -,95 600 6,95 -,75 Druckkosten weitere Farben: siehe Onlineshop MADE GERMANYIN STÜCKAB STÜCK-PREIS 1.DRUCKFARBE 1 6,95 20 6,75 1,80 80 6,50 1,30 150 6,25 -,85 400 5,95 -,75 800 5,75 -,65 1.000 4,95 -,45 Druckkosten weitere Farben: siehe Onlineshop






















































































Lieferung nur für den gewerblichen Bedarf. Alle Preise zzgl. MwSt.72 | NACHHALTIG BESTE BEGLEITER MADE GERMANYIN Scharfes Messer 100% biobasiertesMaterial inkl. SpruchStandardDRUCK4CORGANIC USE ORGANIC USE DRUCK4C 1 KOZIOL ISO TO GO BECHER ISO TO GO begeistert durch seinen natürlichen Look und die hohe Funktionalität. Der doppelwandige Kaffeebecher sorgt für optimale Isolation und verfügt über einen flexibel und somit perfekt sitzenden Deckel. Bruchsicher und spülmaschinengeeignet dank innovativem, 100% biobasiertem Material. 100% recycelbar, Melamin- und BPA-frei. 100% Klimaneutral. Zero Waste beginnt genau hier. S Siebdruckdruck. Fläche: 150 x 40 Preis/Stk.:mmab 12 Stück 3,Werkzeugkosten: Siehe Serviceseiten. 220 734 braun ab 7,95 220 792 grau ab 7,95 220 759 rot ab 7,95 220Standardmotive767Lieblingsmensch 12,95 220 775 Hellwach 12,95 220 783 Montag ist... 12,95 2 KOZIOL KLIKK POCKET READY KLIKK POCKET READY besteht aus dem KLIKK ETUI, eine schlanke Box die nur wenig Platz benötigt und dem Besteck-Set KLIKK POCKET. Messer, Gabel, Löffel werden einfach ineinandergesteckt und passen dank ihrer kompakten Größe in jede Jackentasche. Zum Öffnen einfach auf den Knopf drücken und alle Teile lösen sich ganz leicht voneinander. Die Besteckteile liegen gut in der Hand und sind extrem robust. Das Material ist besonders langlebig, dazu geschmacksneutral, lebensmittelecht und spülmaschinenfest. Die Box hat einen praktischen Clipverschluss und lässt sich problemlos in der Spülmaschine reinigen. Ein sinnvolles Konzept für alle, die kompromisslos nachhaltig genießen wollen. W Werbedruck. Fläche: auf Etui 80 x 20 mm Preis/Stk.: ab 12 Stück 2,95 Werkzeugkosten: Siehe Serviceseiten. D Digitaldruck. Fläche: auf Etui 180 x 20 mm Preis/Stk.: ab 12 Stück 4,95 Datenhandling: einmalig 29,220 806 organic grey ab 7,95 220 814 organic green ab 7,95 STÜCKAB STÜCKPREIS 1.DRUCKFARBE 1 11,95 12 11,45 3,25 10,95 1,80 50 9,95 1,50 100 9,75 1,20 250 8,95 -,95 500 7,95 -,75 Druckkosten weitere Farben: siehe Onlineshop STÜCKAB STÜCKPREIS 1.DRUCKFARBE DIGITAL4C Druckkosten1002512110,95–10,452,954,959,952,504,45509,451,953,758,951,452,952507,95-,951,95weitereFarben:sieheOnlineshop 1 KOZIOL ISO TO GO BECHER ab 7 95 2 KLIKKKOZIOLPOCKET READY ab 7 95 1 KOZIOL ISO TO GO STANDARDMOTIVEBECHER 12 95


























































































































































































NATÜRLICH UNTERWEGS 100% RECYCLEBAR MADE GERMANYIN USEFREE medium large 2 GLASFLASCHE ECO-DRINK Glas-Trinkfl asche mit WeizenstrohUmmantelung, Schraubverschluss und Trageschlaufe, bestehend aus nachwachsenden Rohstoffen (30% Weizenstroh, 70% PP und Glas). Füllmenge: ca. 300 ml Maße: Ø 6 x 20 cm W Werbedruck. Fläche: auf Vorderseite 20 x 70 mm Preis/Stk.: ab 50 Stück -,80 Werkzeugkosten: Siehe Serviceseiten. 220 172 beige ab 1,69 220 189 blau ab 1,69 220 197 rot ab 1,69 STÜCKAB STÜCKPREIS 1.DRUCKFARBE 1 2,95 50 2,75 -,80 100 2,55 -,70 250 2,25 -,60 500 1,95 -,50 1.000 1,85 -,40 2.500 1,69 -,30 Druckkosten weitere Farben: siehe Onlineshop USE 2 ECO-DRINKGLASFLASCHE ab 1 69 73NACHHALTIG | 1 MENÜBOX TO GO Mit diesen neuen To-Go-Boxen ist Schluss mit der unnötigen Müllproduktion. Sie ist die nachhaltige Alternative zu Einwegverpackungen und bietet warmen und kalten Speisen genug Platz, um darin sicher transportiert und verspeist zu werden. Inneneinteilung in 3 Fächer. Wiederverwendbar, zu 100% recycelbar und natürlich BPA-frei. Für die Mikrowelle, Spülmaschine und den den Kühlschrank geeignet. Maße: Medium 24,6 x 15,7 x 10,4 cm, Large: 25,2 x 20,3 x 13,1 cm W Werbedruck. Fläche: 100 x 50 mm Preis/Stk.: ab 40 Stück -,85 Werkzeugkosten: Siehe Serviceseiten. D Digitaldruck 4c. Fläche: 150 x 100 mm Preis/Stk.: ab 40 Stück 1,85 Datenhandling: einmalig 29,Medium 212 978 grün ab 2,49 212 986 braun ab 2,49 212 994 blau ab 2,49 Large 213 028 grün ab 3,49 213 036 braun ab 3,49 213 044 blau ab 3,49 1 TOMENÜBOXGO ab 2 49 STÜCKAB MEDIUMBOX LARGEBOX 1.DRUCKFARBE DIGITAL4C 1.000500250150804014,055,35–3,754,95-,851,853,554,65-,751,653,454,35-,651,453,254,15-,551,202,953,75-,45-,952,493,49-,35-,70DruckkostenweitereFarben:sieheOnlineshop



































ab 2 95 Lieferung nur für den gewerblichen Bedarf. Alle Preise zzgl. MwSt.74 | NACHHALTIG 1 GLAS FLASCHE „TAKE JUTY“ 450 ml Geschmacks- und geruchsneutral sowie garantiert BPA-frei: Wiederverwendbare Trinkflasche aus Glas, sicher verpackt in einer isolierenden Schutzhülle. Spülmaschinengeeignet ohne Deckel und Mantel. Füllmenge: 450 ml Maße: Ø 6,5 x 18,5 cm SP Spezialsiebdruck. Fläche: auf Hülle 40 x 70 mm Preis/Stk.: ab 70 Stück -,95 Werkzeugkosten: Siehe Serviceseiten 214 199 natur ab 1,79 214 203 grau ab 1,79 214 211 blau ab 1,79 214 220 rot ab 1,79 1 GLAS FLASCHE „TAKE JUTY“ ab 1 79
MIT GEWISSENGUTEMIN DEN TAG STARTEN STÜCKAB STÜCK-PREIS 1.DRUCKFARBE 1 3,10 70 2,85 -,95 1502,55 -,80 300 2,35 -,70 5002,05 -,50 1.000 1,95 -,35 2.0001,85 -,25 5.000 1,79 -,20 Druckkosten weitere Farben: siehe Onlineshop 2 WEIZENSTROH-TRINKFLASCHEMETMAXX MIT GLASEINSATZ 550 ml Nachfüllen, um Müll zu vermeiden. Praktische und handliche Glastrinkfl asche aus Thermoglas im resourcenschonenden Bioplastikkorpus für unterwegs, im Alltag und Büro. Verschließbarer, auslaufgeschützter Deckel inklusive Trageschlaufe. Maße: Ø 7,6 x 19,5 cm W Werbedruck. Fläche: seitlich 30 x 40 mm Preis/Stk.: ab 25 Stück 1,15 S Siebdruck. Fläche: rundum 220 x 100 mm Preis/Stk.: ab 25 Stück 1,55 Werkzeugkosten: Siehe Serviceseiten. 214 300 ab 2,95 STÜCKAB STÜCKPREIS 1.DRUCKFARBE DRUCKSIEBDruckkosten2.0001.0002001002514,95––4,551,151,554,251,051,454,10-,951,204003,90-,851,053,45-,75-,952,95-,65-,85weitereFarben:sieheOnlineshop
Mit Glaseinsatz 2 METMAXX TRINKFLASCHEWEIZENSTROH-MITGLASEINSATZ


























2 NOTIZBUCH WEIZENSTROH ab 2 45 1 KORK NOTIZBUCHHAFTab 0 95 75NACHHALTIG | 3 NOTIZBUCH „TAIFOR“ Notizblock mit Bezügen aus weichem Polyester auf Hardcover. In vier trendigen Farben. 80 A5 Seiten. Maße: 12,5 x 17,1 x 1,3 cm / A5 W Werbedruck. Fläche: 60 x 40 Preis/Stk.:mmab 50 Stück -,80 Werkzeugkosten: Siehe Serviceseiten. 220 113 grün ab 1,49 220 121 blau ab 1,49 220 130 orange ab 1,49 220 148 rot ab 1,49 STÜCKAB STÜCKPREIS DRUCK1C 1 2,50 50 2,25 -,80 100 2,15 -,70 250 2,05 -,60 500 1,95 -,50 1.000 1,75 -,40 2.000 1,49 -,30 3 NOTIZBUCH „TAIFOR“ ab 1 49 2 NOTIZBUCH WEIZENSTROH Notizbuch mit Hardcover-Abdeckung aus Weizenstroh und Recyclingpapier sowie ein Kugelschreiber aus Weizenstroh und PP. 80 A5 Seiten. Maße: 13,5 x 17,9 x 1,8 cm / A5 W Werbedruck. Fläche: 75 x 40 Preis/Stk.:mmab 30 Stück 1,20 Werkzeugkosten: Siehe Serviceseiten. 220 105 ab 2,45 STÜCKAB STÜCKPREIS 1.DRUCKFARBE 1 3,95 30 3,75 1,20 100 3,55 1,250 3,40 -,80 500 3,25 -,70 1.000 2,95 -,50 1.500 2,45 -,30 Druckkosten weitere Farben: siehe Onlineshop 1 KORK HAFTNOTIZBUCH Haftnotizbuch mit farbigem Gummiband und Umschlag aus natürlichem Kork. Bietet im Inneren Haftnotizen in drei Größen und sieben Farben. Maße: 8 x 15,5 x 1 cm W Werbedruck. Fläche: 50 x 30 Preis/Stk.:mmab 100 Stück -,45 Werkzeugkosten: Siehe Serviceseiten. 187 361 blau ab -,95 187 370 rot ab -,95 187 388 grün ab -,95 STÜCKAB STÜCK-PREIS 1.DRUCKFARBE 1 1,45 100 1,35 -,45 2501,25 -,40 500 1,15 -,35 1.0001,05 -,30 2.000 -,95 -,25 Druckkosten weitere Farben: siehe Onlineshop






















































































































2 GLAS BAMBOO ART 350ml In diesem doppelwandigem Glasbecher mit Deckel halten Getränke besonders lange die gewünschte Temperatur. Der Deckel ist aus nachhaltigem Bambus und verschließt den Becher dank Gummiring besonders dicht. Maße: Ø 9 x 12 cm W Werbedruck. Fläche: Ø 65 mm Preis/Stk.: ab 20 Stück 1,60 L Lasergravur. Fläche: Ø 50 mm Preis/Stk.: ab 20 Stück 2,20 Werkzeugkosten: Siehe Serviceseiten. 210 530 ab 4,29 GLAS BAMBOO ART ab 4 29 STÜCKAB STÜCK-PREIS 1.DRUCKFARBE GRAVURLASERDruckkosten2001002016,29–5,951,602,20505,751,301,905,551,051,605,19-,951,305004,65-,801,058004,29-,60-,85weitereFarben:sieheOnlineshop USE 350 ml 1 KAFFEEBECHER„DOSSA“ ab 1 99 1 KAFFEEBECHER „DOSSA“ Leichter Kaffeebecher für umwelbewusste Genießer. Die Becherummantelung ist aus Kork während die Innenseite sowie der Deckel mit Trinköffnung aus Weizenfaser & PP bestehen. Maße: Ø 8,5 x 11 cm W Werbedruck. Fläche: Vorderseite 20 x 50 mm Preis/Stk.: ab 35 Stück 1,20 S Siebdruck. Fläche: Vorderseite 150 x 40 mm Preis/Stk.: ab 35 Stück 1,20 Werkzeugkosten: Siehe Serviceseiten. 220 164 ab 1,99 STÜCKAB STÜCKPREIS 1.DRUCKFARBE 1 3,75 35 3,42 1,20 100 3,25 -,95 250 3,05 -,85 500 2,85 -,70 1.000 2,65 -,50 2.500 2,35 -,30 4.000 1,99 -,20 Druckkosten weitere Farben: siehe Onlineshop SCHON GEWUSST? Die Deutschen nutzen für Heißgetränke jährlich 2,8 Milliarden Einwegbecher. Oft landen die Becher und Deckel nach kurzer Zeit in der Umwelt, weil sie achtlos weggeworfen werden. Mehrwegbecher sind hier die richtige Lösung. Lieferung nur für den gewerblichen Bedarf. Alle Preise zzgl. MwSt.76 | NACHHALTIG









































thermobeständigem Borosilikatglas behalten in dieser Flasche sowohl Heißgetränke als auch kalte Erfrischungen über Stunden die optimale Trinktemperatur. LFGB-konform mit Edelstahldeckel, Teesieb und abnehmbarer Thermomanschette, verpackt in einem Designkarton. Maße: Ø 7,7 x 21,8 cm SP Spezialsiebdruck. Fläche: 100 x 60 mm auf Thermomanschette Preis/Stk.: ab 12 Stück 2,95 Werkzeugkosten: Siehe Serviceseiten. 205 455 ab 6,95 STÜCKAB STÜCK-PREIS 1.DRUCKFARBE 1 10,95 12 9,95 2,95 24 9,45 2,50 48 8,95 2,20 100 8,45 1,80 200 7,95 1,40 500 6,95 -,95 Druckkosten weitere Farben: siehe Onlineshop
Die erste Thermoflasche mit herausnehmbarem Teesieb! Dank
MILLILITER750 USE USE 77NACHHALTIG | TRINKEN TO GO UMWELTSCHONENDUNDSTYLISCH 1 REFILLWASSERFLASCHEMETMAXX„GENERATIONGOURMET“ ab 6 95 2 GLASFLASCHE „TAKE WELL“, 450 ml Geschmacks- und geruchsneutral sowie garantiert BPA-frei: Wiederverwendbare Trinkflasche aus Glas, sicher verpackt in einer isolierenden Schutzhülle. Spülmaschinengeeignet ohne Deckel und Mantel. Füllmenge: 450 ml Maße: Ø 6,5 x 18,5 cm SP Spezialsiebdruck. Fläche: auf Hülle 40 x 70 mm Preis/Stk.: ab 60 Stück -,90 Werkzeugkosten: Siehe Serviceseiten 194 256 blau ab 1,49 194 264 rot ab 1,49 194 272 grün ab 1,49 194 289 orange ab 1,49 200 153 dunkelblau ab 1,49 206 945 weiß ab 1,49 206 953 schwarz ab 1,49 STÜCKAB STÜCK-PREIS 1.DRUCKFARBE 1 2,35 60 2,15 -,90 1502,05 -,80 300 1,95 -,70 5001,85 -,50 1.000 1,65 -,40 2.0001,49 -,30 Druckkosten weitere Farben: siehe Onlineshop 2 „TAKEGLASFLASCHEWELL“ ab 1 49 1 METMAXX REFILL„GENERATIONWASSERFLASCHEGOURMET“,750ML































































3 TRINKHALM TO GO MIT KARABINER Für alle, die weder auf einen Trinkhalm verzichten noch die Umwelt belasten möchten: Dieser wiederverwendbare Trinkhalm lässt sich bei Bedarf auseinanderziehen. Nach Gebrauch einfach mit der beiliegenden Bürste reinigen, zusammenschieben und im Kunststoffetui verpacken. Mit Silikonspitze
für mehr Trinkgenuss und praktischen Karabinerhaken. Maße: 11 x Ø 1,5 cm W Werbedruck. Fläche: 50 x 8 mm Preis/Stk: ab 50 Stück -,70 Werkzeugkosten: Siehe Serviceseiten. 198 209 blau ab 1,45 198 217 rot ab 1,45 198 225 transparent ab 1,45 STÜCKAB STÜCK-PREIS 1.DRUCKFARBE 1 3,25 30 2,95 1,50 50 2,75 1,20 150 2,45 -,95 500 2,25 -,50 1.000 1,95 -,35 Druckkosten weitere Farben: siehe Onlineshop STÜCKAB STÜCK-PREIS 1.DRUCKFARBE 1 2,45 50 2,25 -,70 150 1,95 -,65 500 1,75 -,40 1.500 1,45 -,30 Druckkosten weitere Farben: siehe Onlineshop 3 TRINKHALM TO GO MIT KARABINER ab1 45
INBAMBUS-TRINKHALMEBAMBUS-BOX
SCHON GEWUSST? Ursprünglich wurden Trinkhalme aus Stroh hergestellt. Daher kommt auch der heute noch gebräuchliche Name „Strohhalm“. Erfunden wurde der Strohhalm vermutlich schon 3.000 v. Chr. STÜCK10 Mundstück aufvonTeleskopisch8cm20cm Edelstahlaus USE USE Lieferung nur für den gewerblichen Bedarf. Alle Preise zzgl. MwSt.78 | NACHHALTIG 1 TRINKHALMEPAPIERab0 25 2 BAMBUS-TRINKHALMEINBAMBUS-BOX ab1 95 1 PAPIERTRINKHALME 10er Set Design und Umweltschutz in perfektem Einklang: Trinkhalme aus Papier in ansprechendem Streifendesign für noch mehr Trinkgenuss. Maße: 3,5 x 20 x 1,4 cm W Werbedruck auf Box. Fläche: 60 x 12 Preis/Set:mmab 300 Set -,18 Werkzeugkosten: Siehe Serviceseiten. 200 400 weiß/ blau ab -,25 200 418 weiß/ rot ab -,25 2
Ein Trinkhalm aus Bambus bietet Trinkgenuss mit besonders gutem Gewissen. Dank passender Bürste können die Trinkhalme ganz einfach gereinigt und immer wieder verwendet werden. Mit praktischer Aufbewahrungsbox –natürlich ebenfalls aus Bambus. Inhalt: 3 verschiedene Stärken Maße: Box 21 x Ø 3 cm W Werbedruck. Fläche: 80 x 15 mm Preis/Stk: ab 30 Stück 1,50 Werkzeugkosten: Siehe Serviceseiten. 198 250 ab 1,95 SETAB PREISSET- 1.DRUCKFARBE 1 -,39 300 -,35 -,18 600 -,32 -,16 1.500 -,29 -,14 2.500 -,27 -,12 5.000 -,25 -,10 Druckkosten weitere Farben: siehe Onlineshop

























































































4x Trinkhalm + Bürste TEILE4 3 SILIKONTRINKHALM„PRACTICALLY“ ab 0 49 100STÜCK USE DRUCK4C USE USE 79NACHHALTIG | 4 TRINKHALM „ DRINK ELEGANT“ ab 1 29 4 TRINKHALM „DRINK ELEGANT“ Umweltbewusste Alternative zum Plastik-Einwegtrinkhalm: dieser EdelstahlTrinkhalm. Er kann mit beiliegender Bürste ganz einfach gereinigt werden. Inklusive Baumwollbeutel zur perfekten Platzierung Ihrer Werbebotschaft. Maße:24 x 6,5 cm, Trinkhalm 21,7 cm SP Fläche:Spezialsiebdruck. 130 x 40 mm Preis/Stk.: ab 50 Stück -,80 Werkzeugkosten: Siehe Serviceseiten. 191 527 ab 1,29 3 SILIKON „PRACTICALLY“TRINKHALM Die leuchtenden Trinkhalme aus flexiblem Silikon haben einen extra großen Durchmesser und sind damit auch für Smoothies, Proteinshakes & Co. bestens geeignet. Nach Gebrauch einfach waschen. Maße: Box Ø 5,5 x 2 cm, Trinkhalm 25,5 cm. W Werbedruck. Fläche: Ø 40 mm Preis/Stk.: ab 150 Stück -,28 Werkzeugkosten: Siehe Serviceseiten. D Digitaldruck 4c. Fläche: Ø 40 mm Preis/Stk.: ab 150 Stück -,60 Datenhandling: einmalig 29,191 650 grün ab -,49 191 668 orange ab -,49 191 633 blau ab -,49 191 641 rot ab -,49 STÜCKAB STÜCK-PREIS 1.DRUCKFARBE 1 1,95 50 1,85 -,80 100 1,75 -,75 300 1,60 -,65 600 1,50 -,60 1.500 1,40 -,50 2.500 1,29 -,40 Druckkosten weitere Farben: siehe Onlineshop STÜCKAB STÜCK-PREIS 1.DRUCKFARBE DIGITAL4C Druckkosten5.0002.0008004001501-,79–-,72-,28-,60-,69-,25-,50-,59-,20-,45-,54-,15-,40-,49-,12-,35weitereFarben:sieheOnlineshop 1 EDELSTAHL TRINKHALM „DRINK HAPPY“, SET / 4 STK. Weniger Plastikabfall, mehr Trinkvergnügen! Die vier leicht gebogenen Trinkhalme sind aus Edelstahl und können dank passender Reinigungsbürste immer wieder verwendet werden. Im Baumwollbeutel. Maße: Ø 0,6 x 21,5 cm SP Spezialsiebdruck. Fläche: auf Beutel 130 x 40 mm Preis/Stk.: ab 40 Stück -,95 Werkzeugkosten: Siehe Serviceseiten. 194 297 ab 1,99 1 EDELSTAHL TRINKHALM „DRINK HAPPY“ ab 1 99 SETAB STÜCK-PREIS 1.DRUCKFARBE 403,0513,25 -,95 802,95 -,75 1502,85 -,65 5002,55 -,55 1.0002,25 -,35 2.5001,99 -,25 Druckkosten weitere Farben: siehe Onlineshop TRINKEN GANZ IM SINNE DER NACHHALTIGKEIT 2 PAPIERTRINKHALME 100er Set natur Denn diese Trinkhalme (Länge 20 cm) sind aus biologisch abbaubarem Naturpapier. Maße Box : 11 x 20,5 x 3,5 cm W Werbedruck auf Box. Fläche: 80 x 30 Preis/Set:mmab 50 Set -,70 Werkzeugkosten: Siehe Serviceseiten. 200 395 natur ab 1,29 SETAB PREISSET- 1.DRUCKFARBE 1 2,15 50 1,95 -,70 150 1,85 -,60 500 1,65 -,50 1.000 1,29 -,40 Druckkosten weitere Farben: siehe Onlineshop 2 PAPIERTRINKHALME ab1 29






























































































MITMETALL-BROTDOSEBAMBUSDECKEL
Das hochwertige Schneidbrett für die Küche mit einer Stärke von 8 mm ist aus Bambus gefertigt, welcher nicht nur messerschonend und widerstandsfähig ist, sondern auch unter ökologischen Aspekten klare Vorteile bietet. Wie bei allen Holzbrettern wird die Reinigung per Hand empfohlen. Maße: klein 24,5 x 17,5 x 0,8 cm, groß 32 x 20 x 1,2 cm L Lasergravur. Fläche: Klein: 50 x 30 mm Preis/Stk.: ab 40 Stück 1,95 Groß: 60 x 40 mm Preis/Stk.: ab 25 Stück 2,15 Werkzeugkosten: Siehe Serviceseiten. 220 357 klein ab 1,95 220 365 groß ab 3,95
3 SCHÜRZE
Serviceseiten. 220 332 klein ab 8,95 220 349 groß ab10,95
Schürze ist nicht nur bequem, langlebig und nachhaltig, sie ist dank der 2 Fronttaschen auch sehr nützlich. Maße: 65 x 90 cm SP Siebdruck-Transfer. Fläche: Oberhalb der Tasche 200 x 70 mm Preis/Stk.: ab 15 Stück 2,50 Werkzeugkosten: Siehe Serviceseiten. 220 488 schwarz ab 3,95 220 902 inkl. personalisierungEinzelnamen- 12,95 STÜCKAB KLEINPREIS GROSSPREIS WERBE-DRUCK GRAVURLASERDruckkosten10025113,9516,95––812,9515,953,503,7012,4514,951,953,205011,9513,951,752,8510,4512,451,502,652509,9511,951,252,455008,9510,95-,952,25weitereFarben:sieheOnlineshop STÜCKAB STÜCKPREISKLEIN GRAVURLASER1 3,25 40 2,95 1,95 100 2,75 1,75 250 2,45 1,55 500 2,25 1,25 1.000 1,95 -,95 Druckkosten weitere Farben: siehe Onlineshop STÜCKAB STÜCKPREISGROSS GRAVURLASER1 5,25 25 4,95 2,15 50 4,75 1,95 100 4,45 1,75 250 4,25 1,45 500 3,95 1,15 Druckkosten weitere Farben: siehe Onlineshop STÜCKAB STÜCKPREIS 1.DRUCKFARBE 1 6,50 15 6,20 2,50 30 5,95 1,95 100 5,45 1,40 250 4,95 -,95 500 3,95 -,70 Druckkosten weitere Farben: siehe Onlineshop 1 MITMETALL-BROTDOSEBAMBUSDECKEL ab 8 95 2 SCHNEIDBRETT BAMBOO ab 1 95 3 SCHÜRZE ab 3 95 Lieferung nur für den gewerblichen Bedarf. Alle Preise zzgl. MwSt.80 | NACHHALTIG
Nachhaltige Brotzeitbox für Werbung. Die Dose besteht aus Aluminium, der Deckel ist Bambusholz und verfügt über einen samt Klemmbügel ein sicheres Verschließen. Der Deckel ist komplett abnehmbar und kann bei Bedarf als Schneidbrett verwendet werden. Maße: klein groß 23 W Fläche: klein 90 L Lasergravur. 90 Werkzeugkosten: Siehe
x 40 mm, groß 110 x 50 mm Preis/Stk.: ab 8 Stück 3,70
Ihre
für
BAMBOO
Küchenschürze mit 2 Fronttaschen aus 100% Organic Cotton 200 g/m². Diese
aus
Silikonring
Werbedruck.
17 x 11,7 x 5,7 cm,
x 15 x 7 cm
x 40 mm, groß 110 x 50 mm Preis/Stk.: ab 8 Stück 3,50
auch
2 SCHNEIDBRETT
Fläche: klein
GENUSSNACHHALTIGER Lange Schürze In 2 Größen Groß: 32 x 20 x 1,2 cm Klein: 24,5 x 17,5 x 0,8 cm 90 cm 1






























































































































TEILE3 2 LUNCHBOX „ROSILI“, mit Deckel aus Bambus Lunchbox mit Deckel aus Bambus für eine stilvolle Werbeanbringung. Die Glasschale ist für Mikrowelle und Backofen geeignet Füllmenge: ca. 350 ml (klein), ca. 1060 ml (groß) Maße: 14,8 x 10,7 x 5,8 cm (klein), 19,7 x 14,5 x 6 cm (groß) W Werbedruck. Fläche: klein: 100 x 50 mm auf Deckel Preis/Stk.: ab 25 Stück 1,40 groß: 120 x 70 mm auf Deckel Preis/Stk.: ab 15 Stück 2,50 L Lasergravur. Fläche: klein: 100 x 70 mm auf Deckel Preis/Stk.: ab 25 Stück 2,30 groß: 140 x 80 mm auf Deckel Preis/Stk.: ab 15 Stück 2,80 Werkzeugkosten: Siehe Serviceseiten. 206 961 350 ml ab 3,65 206 970 1060 ml ab 6,49 STÜCKAB STÜCK-PREIS 1.DRUCKFARBE GRAVURLASERDruckkosten800300150602515,65–5,401,402,305,151,202,104,951,051,904,40-,951,503,65-,751,20weitereFarben:sieheOnlineshop Lunchbox klein (ca. 350 ml): STÜCKAB STÜCK-PREIS 1.DRUCKFARBE GRAVURLASERDruckkosten5002001001519,45–8,952,502,80408,751,502,-8,451,101,707,45-,951,506,49-,751,30weitereFarben:sieheOnlineshop Lunchbox groß (ca. 1060 ml): 2 350„ROSILI“LUNCHBOXML ab 3 65 2 1060„ROSILI“LUNCHBOXML ab 6 49 1060 ML USEUSE 81NACHHALTIG | 1 BAMBUS „NATUREBESTECKTRIP“ Nie wieder Einwegplastik für unterwegs! Das Besteck-Set aus natürlichem Bambus ist ideal für Reisen, Ausflüge und Picknicks und kann tausendfach wiederverwendet werden. Mit praktischem Baumwoll-Säckchen. Maße: 22 x 6,5 cm SP Fläche:Spezialsiebdruck. 130 x 40 mm auf den Beutel Preis/Stk.: ab 75 Stück -,75 Werkzeugkosten: Siehe Serviceseiten. 200 215 ab 1,09 STÜCKAB STÜCK-PREIS 1.DRUCKFARBE 1 1,95 75 1,85 -,75 150 1,65 -,70 500 1,45 -,65 1.5001,25 -,55 2.500 1,09 -,45 Druckkosten weitere Farben: siehe Onlineshop 1 BAMBUS „NATUREBESTECKTRIP“ ab 1 09




























































Lieferung nur für den gewerblichen Bedarf. Alle Preise zzgl. MwSt.82 | NACHHALTIG ÖKOLOGISCHE UNTERWEGS MIT GUTEM GEWISSEN WERBEN 1 SONNENBRILLE NATURE STYLE Überwiegend aus nachwachsenden Rohstoffen bestehende Sonnenbrille mit dunkler Glastönung und UV 400 Zertifizierung. Perfekter Werbedruck auf den Bügeln. Einheitsgröße. Material: Bambus, Kunststoff, Polyacryl W Werbedruck. Fläche: 40 x 7 mm auf einen Preis/Stk.:Bügelab150 Stück -,40 Werkzeugkosten: Siehe Serviceseiten. 201 685 natur ab -,59 201 693 schwarz ab -,59 201 708 blau ab -,59 201 716 rot ab -,59 STÜCKAB STÜCK-PREIS 1.DRUCKFARBE 1 -,99 150 -,89 -,40 300 -,85 -,35 1.000-,79 -,30 2.500 -,69 -,25 5.000-,59 -,20 Druckkosten weitere Farben: siehe Onlineshop 3 BAMBUSEINKAUFSWAGENAUSLÖSER Auf diesem Einkaufswagenauslöser aus Bambus hinterlassen Sie mit Ihrem Unternehmenslogo einen besonders nachhaltigen Eindruck bei Ihren Kunden. Maße: 7,3 x 2,3 x 0,2 cm (ohne Schlüsselring) W Werbedruck. Fläche: 40 x 11 Preis/Stk.:mmab 300 Stück -,18 L Lasergravur. Fläche: 40 x 11mm Preis/Stk.: ab 300 Stück -,36 Werkzeugkosten: Siehe Serviceseiten. 204 997 ab -,39 STÜCKAB STÜCK-PREIS 1.DRUCKFARBE GRAVURLASER10.0005.0002.500-,461.000600-,573001-,69–-,60-,18-,36-,17-,34-,52-,16-,32-,15-,30-,42-,14-,29-,39-,13-,28DruckkostenweitereFarben:sieheOnlineshop 1 NATURESONNENBRILLESTYLE ab 0 59 3 AUSLÖSEREINKAUFSWAGEN-BAMBUS ab 0 39 2 BAMBOOSONNENBRILLELINE ab 2 75 2 SONNENBRILLE BAMBOO LINE Die perfekte Werbefl äche für heiße Sommertage: Auf den Bambusbügeln der dunkel getönten UV 400 zertifizierten Sonnenbrille mit schwarzem Kunststoffrahmen wird Ihre Werbebotschaft bestens in Szene gesetzt. Maße: Einheitsgröße 14,5 cm W Werbedruck. Fläche: 30 x 6 mm Preis/Stk: ab 40 Stück 1,20 Werkzeugkosten: Siehe Serviceseiten. 196 387 ab 2,75 STÜCKAB STÜCK-PREIS 1.DRUCKFARBE 1 4,95 40 4,55 1,20 100 4,05 1,10 250 3,55 1,500 3,25 -,85 1.000 2,95 -,70 2.500 2,75 -,40 Druckkosten weitere Farben: siehe Onlineshop 4 BAMBUS ZAHNBÜRSTE HELL Mit dieser Zahnbürste aus dem biologisch abbaubaren und nachhaltigen Rohstoff Bambus mit angenehmen Nylon-Borsten können Sie aktiv dazu beitragen, den Plastikmüll zu reduzieren. Maße: 19 x 2 cm W Werbedruck. Fläche: 60 x 6 mm Preis/Stk.: ab 200 Stück -,23 L Lasergravur. Fläche: 60 x 6 mm Preis/Stk.: ab 200 Stück -,39 Werkzeugkosten: Siehe Serviceseiten. 210 513 ab -,39 4 BAMBUS ZAHNBÜRSTE HELL ab 0 39 STÜCKAB STÜCK-PREIS 1.DRUCKFARBE GRAVURLASERDruckkosten10.0005.0002.5001.0005002001-,59–-,56-,23-,39-,53-,21-,35-,50-,19-,29-,47-,17-,25-,44-,15-,19-,39-,13-,16weitereFarben:sieheOnlineshop UP USE








































BLUMENWIESEN HAUS Ein schönes Geschenk und persönliches Statement zugleich! Gehen Sie aktiv gegen das Bienensterben vor – dieses Haus bietet alles, was dafür benötigt wird: Anzuchterde, zwei Anzuchttöpfe und Samen, mit denen Sie eine Blumenwiese im Topf oder auf einer Freifläche ziehen und Bienen eine tolle Mahlzeit bereiten können. Mit ganz viel Liebe in Werkstätten für Menschen mit Behinderung hergestellt. Maße: 9 x 15,5 x 9 cm 204 190 6,95
und
Maße: 6 x 15 x 4 cm 204 181 3,95
3 KRÄUTER GARTEN HAUS 6 95 1 WILDBIENENHOTEL MINI 3 95 2 HAUSBLUMENWIESEN 6 95
4 „BIRD“VOGELHAUS ab 1 95
1
KRÄUTER GARTEN HAUS L assen Sie den Salat sprießen! Das kleine Gartenhaus aus Naturpappe ist das perfekte Geschenk für alle Salatjunkies sowie Gartenliebhaber und enthält Anzuchttöpfchen, Anzuchterde und Samen für knackig frischen Pflücksalat. Das Häuschen ist handgestempelt und wird liebevoll gefertigt in Werkstätten für Menschen mit Behinderung Maße: 9 x 15,5 x 9 cm 204 204 6,95 4 VOGELHAUS „BIRD“, Bausatz aus Holz Bauen Sie dem Federvieh ein süßes Häuschen. Dieser 7-teilige Bausatz enthält alles, was Sie dafür brauchen. Die Bauteile aus MDF-Holz werden ganz einfach zusammengesteckt, zusätzliches Werkzeug wird nicht benötigt. Maße: 17,0 x 11,8 x 3,1 cm W Werbedruck. Fläche: 45 x 40 mm Preis/Stk.: ab 40 Stück -,95 L Lasergravur. Fläche: 45 x 40 mm Preis/Stk.: ab 40 Stück 1,20 Werkzeugkosten: Siehe Serviceseiten. 205 383 ab 1,95 STÜCKAB STÜCK-PREIS 1.DRUCKFARBE GRAVURLASERDruckkosten2.0001.0002,20-,30-,455002502,70-,50-,901004013,70–3,30-,951,202,90-,601,052,40-,40-,701,95-,25-,35weitereFarben:sieheOnlineshop
2
MADE GERMANYIN 7-teiligerBausatz 83NACHHALTIG |
WILDBIENENHOTEL MINI Bienen sind überaus fleißige Helfer, wenn es um den Erhalt unseres Ökosystems geht. Umso wichtiger ist es, die bedrohten Tiere zu schützen. Dieses Wildbienenhotel aus laminierter Naturpappe, das auch Regen- und Schneeschauer problemlos übersteht, ist mit einem Wabenkarton gefüllt und bietet Wildbienen ideale Unterschlupfmöglichkeiten. Hergestellt wird das Produkt liebevoll in Werkstätten für Menschen mit Behinderung. Zeigen Sie, dass Ihnen die Umwelt am Herzen liegt und machen Sie Geschäftspartner Kunden zu Bienenrettern!
3
























































































MADE GERMANYIN 1 HOLZ BALANCE
in welcher Reihenfolge die sechs farbigen Steine auf die Halbkugel gesetzt werden. Mit Stoffbeutel. Hinweis: Nicht geeignet für Kinder unter 3 Jahren. Maße: 6 x 6 x 13 cm SP Spezialsiebdruck. Fläche: 40 x 11mm Preis/Stk.: ab 70 Stück -,65 Werkzeugkosten: Siehe Serviceseiten. 213 526 ab 1,25 1 BALANCEHOLZ TURM ab 1 25 MADE GERMANYIN STÜCKAB STÜCK-PREIS 1.DRUCKFARBE 1 1,95 70 1,85 -,65 150 1,65 -,55 300 1,55 -,45 600 1,45 -,40 1.500 1,35 -,35 3.000 1,25 -,30 Druckkosten weitere Farben: siehe Onlineshop
21
Lieferung nur für den gewerblichen Bedarf. Alle Preise zzgl. MwSt.84 | NACHHALTIG
UMWELTBEWUSSTES SPIELEN FÜR GROSS UND KLEIN fördertdieMotorikMotorik
2 FANGBECHER GESCHICKLICHKEITSSPIEL HOLZ 4er Set Macht Spaß und fördert die Motorik! „Fang die Kugel“ ist ein überaus beliebtes Geschicklichkeitsspiel bei kleinen Kinder. Gefertigt in Deutschland mit Holz aus heimischen Wäldern. Nicht geeignet für Kinder unter 3 Jahren. Maße: 5 x 8,5 cm 211 321 21,95 3 TANGRAM HOLZ PUZZLE 6er Set Einer der ältesten und beliebtesten Spieleklassiker. Das Tangram-Puzzle bietet Rätselspaß für Kinder und Erwachsene. Mit den 7 Legesteinen aus Holz in den original Tangram-Formen können unzählige Figuren gelegt werden. Der Fantasie sind dabei keine Grenzen gesetzt und das Gehirn wird gleichzeitig trainiert. Nicht geeignet für Kinder unter 3 Jahren. Maße: 11,5 x 11,5 x 0,6 cm 210 923 6,95 2 FANGBECHER LICHKEITSSPIELGESCHICK-HOLZ 95 3 TANGRAM HOLZ PUZZLE 6 95IM6SET TURM 8 Teile Konzentration und Geduld sind hier gefragt! Der Farbwürfel entscheidet,
































































































































NIE MEHR LANGEWEILE UND DAS NACHHALTIGGARANTIERT GARANTIERT 85NACHHALTIG | 1 HOLZ WÜRFEL GEDULDSSPIEL Eine Schlange aus 27 Holzwürfeln rollt sich zusammen und wird zum Würfel. (Wenn man weiß, wie es geht). Ideal für die Reise, da die Teile fest miteinander verbunden sind und deshalb nicht verloren gehen können. Hinweis: Nicht geeignet für Kinder unter 3 Jahren. Maße: 5,4 x 5,4 x 5,4 cm 213 479 4,95 2 HOLZ SPIEL LUDO MINI Handliche Ausführung des Spielklassikers aus Holz mit Steckfi guren. Ideal für unterwegs. Hinweis: Nicht geeignet für Kinder unter 3 Jahren. Maße: 12 x 12 x 2,5 cm 213 487 3,95 3 KUCKUCKSPFEIFE HASELNUSS Made in Germany Ein Spaß mit großem pädagogischen Wert: die Pfeife ahmt originalgetreu den Ruf des Vogels nach! Wer antwortet denn da? Hinweis: Nicht geeignet für Kinder unter 3 Jahren. Maße: 2,5 x 12 cm 213 518 3,95 1 HOLZ GEDULDSSPIELWÜRFEL 4 95 2 HOLZ SPIEL LUDO MINI 3 95 3 HASELNUSSKUCKUCKSPFEIFE 3 95 MADE GERMANYIN

















































































































Lieferung nur für den gewerblichen Bedarf. Alle Preise zzgl. MwSt.86 | NACHHALTIG STÜCK4 STÜCK4 STÜCK4 MADE GERMANYINMADEINGERMANYMADEINGERMANYMADE GERMANYIN WER NICHT WAGT, DER NICHT GEWINNT 1 DELUXESCHWEINEWÜRFEL 9 95 2 SCHWEINE WÜRFEL Set / 4 Stk. Würfeln mal anders: hier wird mit fünf Gummiferkeln gewürfelt. Dabei fallen die Schweine in verschiedene Positionen und erzielen so unterschiedliche Punkte. Wer mit seinem Wurf die höchste Punktzahl erreicht, gewinnt. Maße: Box 6,5 x 5 x 1,3 cm Hinweis: Nicht geeignet für Kinder unter 3 Jahren. 220 662 12,95 1 SCHWEINEWÜRFEL DELUXE Deluxe Leben. Die fünf goldenen Gummischweinchen in der Holzbox haben miteinander viel Spaß, besonders beim Würfeln. Dabei fallen sie in verschiedene Positionen und erzielen so unterschiedliche Punkte. Maße: Box 11,5 x 6 x 4,5 cm Hinweis: Nicht geeignet für Kinder unter 3 Jahren. 220 679 9,95 3 DAS AUTO HOLZ-PUZZLE Set / 4 Stk. Ein Holz-Puzzle aus heimischen Wäldern bereitet immer Freude. Schaffen Sie es, ein Auto aus sieben Teilen zu bauen? Manch ein Fahrzeugkonstrukteur würde Sie beneiden. Maße: Box 6,5 x 5 x 1,3 cm Hinweis: Nicht geeignet für Kinder unter 3 Jahren. 220 687 12,95 4 DAS ZERLEGTE HAUS HOLZ-PUZZLE Set / 4 Stk. Naturbuchenholz aus heimischen Wäldern ist ein toller Baustoff. Ein Fertighäuschen aus fünf Teilen ohne Bauanleitung aufzubauen kann aber zur Herausforderung werden. Maße: Box 6,5 x 5 x 1,3 cm Hinweis: Nicht geeignet für Kinder unter 3 Jahren. 220 695 12,95 2 SCHWEINE WÜRFEL 12 95 3 DAS AUTO HOLZ-PUZZLE 12 95 4 DAS ZERLEGTE HAUS HOLZ-PUZZLE 12 95



























































































































































































87NACHHALTIG | MADE GERMANYGERMANYINMADEINMADEINGERMANY 100STEINE STÜCK4 1 GEMISCHTES PUZZLE SET HOLZ SET / 4 STK. Eine Sammlung verschiedener HolzGeschicklichkeitsspiele zur Freude von Groß und Klein. Jede Box ist eine kleine oder gar eine große Herausforderung. Bitte Zeit einplanen! Maße: 6,5 x 5 x 1,3 cm Hinweis: Nicht geeignet für Kinder unter 3 Jahren. 220 700 12,95 2 BAUSTEINSACK HOLZ Set / 100 Stk. IM BAUMWOLLBEUTEL 100 Bausteine aus Buchenholz im Stoffbeutel. So lässt sich manche Architekten-Karriere starten. Der praktische Baumwollbeutel hilft beim einfachen Aufräumen. Gefertigt in Deutschland, mit Holz aus heimischen Wäldern. Maße: Beutel: 40 x 30 x 10 cm Hinweis: Ab 1 Jahr. 220 718 29,95 3 KEGELKISTE HOLZ Kegeln muss geübt sein! Wer beim letzten Kegelabend mit seiner Leistung unzufrieden war, kann damit in der Arbeitspause seine Fähigkeiten heimlich steigern. Maße: Box 15,5 x 12, x 4 cm Hinweis: Nicht geeignet für Kinder unter 3 Jahren. 220 726 19,95 1 PUZZLEGEMISCHTESSETHOLZ 12 95 2 HOLZBAUSTEINSACK 29 95 3 HOLZKEGELKISTE 19 95




















































































































































































1 MASSAGE/ FASZIENBALL
6 cm
Die ökologische Alternative zu Bällen aus Kunststoff überzeugt auf der ganzen Linie: nachhaltig, umweltfreundlich und natürlich biologisch abbaubar. Dieser Faszienball ist aus nachwachsender europäischer Buche oder Kork gefertigt und mit seiner natürlichen, unbehandelten Oberfläche und hohem Härtegrad ideal für den Büroeinsatz. Mit einer punktgenauen Massage der Faszien – dem Bindegewebe zwischen Haut und Muskeln – lösen sich nicht nur Verspannungen, sondern wird auch die Regeneration Leistungsfähigkeit gefördert.
Maße: Ø 6 cm L Fläche:Lasergravur. 30 x 20 mm Preis/Stk: Buche ab 50 Stück 1,20 Preis/Stk: Kork ab 40 Stück 1,25 Werkzeugkosten: Siehe Serviceseiten. 200 709 Buche ab 1,59 200 717 Kork ab 2,29 STÜCKAB STÜCK-PREIS 1.DRUCKFARBE GRAVURLASERDruckkosten1.0005001003014,65––4,451,151,504,10-,951,303,45-,751,102,95-,55-,95weitereFarben:sieheOnlineshop STÜCKAB STÜCK-PREISBUCHE GRAVURLASER1 2,75 50 2,55 1,20 100 2,35 1,250 2,05 -,75 500 1,85 -,60 1.000 1,65 -,50 2.500 1,59 -,40 Druckkosten weitere Farben: siehe Onlineshop 2 4MASSAGEBEINER ab2 95 1 MASSAGE/FASZIENBALLKORK ab2 29 STÜCKAB STÜCK-PREISKORK GRAVURLASER1 3,85 40 3,70 1,25 100 3,55 1,250 3,35 -,75 500 2,95 -,60 1.000 2,45 -,50 2.500 2,29 -,40 Druckkosten weitere Farben: siehe Onlineshop
SCHON GEWUSST? Dieses nützliche Faszientools finden Verwendung in der Behandlung und Massage der Faszien sowie der Muskulatur und sorgen dafür, dass diese wieder geschmeidig und dehnbar werden. Solch ein Faszientraining lässt sich ideal im Büroalltag einbringen. Lieferung nur für den gewerblichen Bedarf. Alle Preise zzgl. MwSt.88 | NACHHALTIG 1 EUROPÄISCHEFASZIENBALLMASSAGE/ BUCHE ab1 59 2 MASSAGE 4 BEINER aus Europäischer Buche Leichte kreisende Bewegungen über Rücken, Oberschenkel oder Waden reichen und schon entfaltet der Massage-Vierbeiner seine wohltuende Wirkung. Die Muskeln werden gelockert, Verspannungen gelöst und das Bindegewebe ganz nebenbei auch gestrafft. Der Massage-Vierbeiner wird ausschließlich aus nachwachsender europäischer Buche gefertigt. Maße: 12 x 9 x 7,5 cm W Fläche:Werbedruck. 20 x 20 mm oben Preis/Stk: ab 30 Stück 1,15 L Fläche:Lasergravur. 20 x 20 mm oben Preis/Stk: ab 30 Stück 1,50 Werkzeugkosten: Siehe Serviceseiten. 200 725 ab 2,95
und






























SCHON GEWUSST? Für die Produktion dieser WellnessKorkprodukte wird nur hochwertiger Kork aus europäischer Produktion verwendet. Die Korkbäume werden hierzu im Alter von 25 Jahren erstmalig geschält, weitere Ernten erfolgen dann im Abstand von 10 Jahren. Da die Korkbäume in der Regel ein Alter von ca. 200 Jahren oder mehr erreichen können, sind also zahlreiche Ernten möglich. So entstehen umweltfreundliche, langlebige und nachhaltige Korkprodukte, wie diese. FÜRUNDKÖRPERGEIST 89NACHHALTIG | STÜCKAB STÜCKPREIS 1.FARBEDRUCK GRAVURLASER 1 24,95 6 23,95 5,45 6,25 15 22,95 4,45 5,25 30 21,95 2,45 2,95 75 19,95 1,45 1,95 150 17,95 -,95 1,25 Druckkosten weitere Farben: siehe Onlineshop 1 AUSFASZIENROLLEKORK ab 17 95 1 FASZIENROLLE AUS KORK Ideales Tool für Faszientraining, Regeneration und Selbstmassage in den Bereichen Beine, Arme, Rücken und Hüfte. Die Vorteile von Kork als hautfreundliches und nachhaltiges Naturmaterial kommen hier besonders zur Geltung. Maße: 30 x 10 cm W Werbedruck. Fläche: 45 x 120 mm Preis/Stk.: ab 6 Stück 5,45 L Lasergravur. Fläche: 45 x 120 mm Preis/Stk.: ab 6 Stück 6,25 Werkzeugkosten: siehe Serviceseiten. 214 625 ab 17,95






















































200TEILE309 .Lieferung nur für den gewerblichen Bedarf. Alle Preise zzgl. MwSt.90 | WERBESETS 201TEILE ab 119.1 SPIELWAREN-SET*, 201 TEILE • 50 Gummibälle farblich sortiert • 100 Jo-Jo‘s farblich sortiert • 50 Wurfscheiben farblich sortiert Eine bunte Palette vielfältiger WerbeIdeen zu einem Superpreis. Hier ist garantiert für jeden kleinen Kunden das richtige Präsent dabei. Bunte Sporttasche mit Spielzeug gefüllt. Max. Druckfläche: Jo-Jo‘s, Gummibälle Wurfscheibe ca. Ø 110 mm. Hinweis: Inkl. aller Druck- und Vorkosten für Standardschriften. Mehrpreis für Logo/Sonderschriften 13,010 794 inkl. Druck 219,010 639 ohne Druck 119,2 WERBESET KORK, 200 TEILE • 100 Kugelschreiber „Kork“ • 50 Schlüsselanhänger „Palaiseau“ • 50 Notizbücher „Kork“ Machen Sie einen besonders nachhaltigen Eindruck bei Geschäftspartnern und Kunden. Bestens geeignet sind dafür Werbeartikel aus dem neuen Trendmaterial Kork, die umweltbewusst und stylisch zugleich sind. Inkl. aller Druck- und Vorkosten für Standardschriften, einfarbig. Mehrpreis für Logo/Sonderschriften 13,194 971 309-



























































































































MEGASET * Komplettpreis inklusiv einseitigen einfarbigen Werbedruck in Standardschrift auf alle Teile, Logo/Sonderschrift zzgl. 13,-. für Sie dazu: Trolley „Padua“ 91WERBESETS | 1 MEGA-WERBESET*, 1.500 TEILE + GRATIS TROLLEY BORDCASE PADUA • 450 Feuerzeuge, gefrostet, blau, rot & gelb • 450 Kugelschreiber, blau/weiß & rot/weiß • 600 Einkaufschip gefrostet blau, rot & gelb • 1 Trolleykoffer Ein Werbeset-Feuerwerk in 3 Farben! Die Bestseller und die beliebtesten Giveaways zusammen in einem Mega-Promotion-Set garantieren die beste Werbewirkung. Für Sie gratis dazu: ein Bordcase-Trolley! Inkl. aller Druck- und Vorkosten für Standardschriften, einfarbig. Mehrpreis für Logo/Sonderschriften 13,159 001 599,1501TEILE599 .-











DIE FÜRSETSALLE FÄLLE mokano mokano mokano mokanomokano Lieferung nur für den gewerblichen Bedarf. Alle Preise zzgl. MwSt.92 | WERBESETS 525TEILE279 .2 525WERBEARTIKEL-SETTEILE • 175 Parkscheiben mit Reise-Rechner • 175 Kapsel- und Schraubverschlussöffner: Flaschenöffner und Flaschenverschluss zugleich. • 175 Einweg-Gasfeuerzeuge Die Parkscheiben sind nach den Vorschriften des § 41 der StVO. 100% Altpapier, mit dem Umweltengel ausgezeichnet. Rückseite mit Reise-Rechner. Kunststoff. Einweg-Gasfeuerzeuge, mit Kunststoffgehäuse, Doppelkammergastank, Metallschutzkappe, Reibradzündung. Flammenhöhe verstellbar. Hinweis: Ihr Werbedruck ist bereits im Sparpreis inbegriffen. Inkl. aller Druckund Vorkosten für Standardschriften, einfarbig. Logo/Sonderschrift zzgl. 13,133 108 279,1 WERBESET „HANDWERK“ 325 TEILE • 50 Stabila Zollstöcke • 25 Handwerker-Kalender • 250 Logo/Sonderschriftenschriften,Druck-Handwerkdiesebleistift,PackenZimmermannsbleistifteSieesan!ObZimmermanns-ZollstockoderKalender–WerbegeschenkesindidealfürundBaugewerbe.Inkl.allerundVorkostenfürStandard-einfarbig.Mehrpreisfür13,194 922 369,325TEILE369 .-




























































































































































* Komplettpreis inklusiv einseitigen einfarbigen Werbedruck in Standardschrift auf alle Teile, Logo/Sonderschrift zzgl. 13,-. 93WERBESETS | START UP 1 WERBESET* „START UP“, 401 Teile inkl. Einkaufskorb • 350 Kugelschreiber „Swing“ mit Gummi-Griffmanschette • 25 LED-Schlüsselanhänger • 25 Natur-Notizbücher Ein stimmiges Angebot für Ihre nächste Werbekampagne. 400 farbig abgestimmte Werbeartikel, versehen mit Ihrem Werbeaufdruck in einem Einkaufskorb mit Alu-Rahmen. Greifen Sie einfach zu mit diesem Set. Natur-Notizbucher mit Kugelschreiber. Plus trendigen Einkaufskorb Maxi. Klischeekosten inklusive für Standard-Satztext, bei Logo/ Sonderschrift zzgl. 13,134 836 blau 259,134 844 rot 259,134 852 schwarz 259,401TEILE259 .-























































fürGRATISSiedazu:Aktenkoffer Lieferung nur für den gewerblichen Bedarf. Alle Preise zzgl. MwSt.94 | WERBESETS 2 WERBESET*, 601 TEILE, INKL. AKTENKOFFER • 300 Druckkugelschreiber • 150 Einwegfeuerzeuge • 150 RundumKapselhebernützlich:600 überzeugende Werbeträger, handlich verpackt und im mitgelieferten Aktenkoffer gut zu transportieren. 300 Stück Druckkugelschreiber mit abrutschsicherem Griffprofil. Spitze, Klipp und Drücker jeweils schwarz. Schaft immer unifarben abgesetzt. Blauschreibende, auswechselbare Mine. 150 Einwegfeuerzeuge: Kunststoffgehäuse mit Doppelkammergastank. Abgerundete Ecken und Kanten. Reibrad-Zündung aus Metall. Flammenhöhe verstellbar. 150 Kapselheber: Kapsel- und Schraubverschlussöffner, gleichzeitig Flaschenverschluss. Kunststoff. Aktenkoffer: hochwertiges Kunstleder, stabiler Rahmen. Sinnvolle praktische Innenausstattung, gefüttert. Zahlenkombinationsschlösser. Maße: ca. 44 x 32 x 10 cm Hinweis: Die Druckkosten für einfarbigen Werbedruck sowie die Klischeekosten Standardschrift sind in diesem Preis inklusive. Sonderschriften und Logos zzgl. 13,129 968 blau 229,129 976 rot 229,129 984 gelb 229,Aktenkoffer auch einzeln lieferbar: 129AKTENKOFFER941 25,95 1 WERBESET „SOFTTOUCH“, 300 TEILE • 200 Kugelschreiber • 100 GroßeFeuerzeugeMasse,große Klasse! Die samtweiche Softtouch-Oberfläche gibt den Giveaways eine weitere fühlbare Komponente und vermittelt eine besonders hohe Wertigkeit. Preis inklusive einheitlicher, einfarbiger Werbeanbringung für alle Teile bei Standardtext, Aufpreis für Sonderschrift/Logo nur 13,194 891 schwarz 259,194 906 blau 259,194 914 rot 259,300TEILE259 .601TEILE229 .-
















































































































* Komplettpreis inklusiv einseitigen einfarbigen Werbedruck in Standardschrift auf alle Teile, Logo/Sonderschrift zzgl. 13,-. 500TEILE249 .BUSINESS 95WERBESETS | 1 DAS BUSINESS-PAKET, 1 SET / 500 TEILE • 320 Kugelschreiber „Mexico“ • 150 Piezo-Feuerzeuge • 30 Schlüsselanhänger mit LED-Leuchte. Unser Super-Angebot für Ihre nächste Werbekampagne. 500 silberne Teile, versehen mit Ihrem einfarbigen Werbeaufdruck. Keine Berechnung von Klischeekosten für Standard-Satztext, bei Logo/Sonderschrift nur 13,- Aufpreis. 093 629 3-farbig 249,094 068 blau 249,094 076 rot 249,094 084 schwarz 249,-








1 WERBESET* „BUSINESS STARTER“, 300 TEILE • 100 Haftnotizheftchen • 100 Feuerzeuge „Fancy Colours“ in blau, pink, grün, gelb und lila • 100 Kugelschreiber „Sway“ in blau, magenta, grün, rot und gelb Das große Paket für den Einstieg ins Business. Hinweis: inkl. aller Druck- und Vorkosten für Standardschriften, einfarbig. Mehrpreis für Logo/Sonderschriften 13,124 663 169,125TEILE99 .Lieferung nur für den gewerblichen Bedarf. Alle Preise zzgl. MwSt.96 | WERBESETS 300TEILE169 .2 WERBESET „WEISS“, 125 TEILE • 50 Kugelschreiber „Sway“ • 50 Piezo-Feuerzeuge „Atomic F2“ • 25 Haftnotizblöcke Drei Klassiker in weiß: Auf dem weißen Untergrund von Kugel-schreiber, Feuerzeug und Haftnotizblock kommt Ihr Logo besonders gut zur Geltung. Inkl. aller Druck- und Vorkosten in 4C Digitaldruck. 194 939 99,-
































































































* Komplettpreis inklusiv einseitigen einfarbigen Werbedruck in Standardschrift auf alle Teile, Logo/Sonderschrift zzgl. 13,-. 97WERBESETS | 1 METALLIC-WERBESET „SHINY“, 310 TEILE • 10 hochwertige Taschenlampen mit 9 weißen LED‘s • 100 Feuerzeuge „Light & Fire“ mit Piezo-Zündung sowie weißer Leucht-LED • 200 Kugelschreiber „Glitzer“, alle im passenden Look Die Taschenlampen werden mit 3 im Lieferumfang enthaltenen Micro-Batterien betrieben. Preis inklusive einheitlicher, einfarbiger Werbeanbringung für alle Teile bei Standardtext, Aufpreis für Sonderschrift/Logo nur 13,103 771 silber 249,103 780 blau 249,103 798 rot 249,310TEILE249 .-














Lieferung nur für den gewerblichen Bedarf. Alle Preise zzgl. MwSt.98 | WERBESETS 1 WERBESET „LASERGRAVUR“ 200 TEILE • 100 Flaschenöffner • 100 LassenKugelschreiberSieIhrenguten Namen sprechen – und das gleich 200-mal! Als edle Lasergravur auf diesen hochwertigen Flaschenöffnern und Kugelschreibern aus matt gebürstetem Aluminium. Inkl. aller Druck- und Vorkosten mit Lasergravur 194 859 schwarz 139,194 867 rot 139,194 875 blau 139,GRAVURLASER 200TEILE139 .2 WERBESET „GÜNSTIG“, 175 TEILE • 75 Metall-Kugelschreiber • 50 Feuerzeuge • 50 LED-Taschenlampen So individuell wie Ihre Kunden sind auch unsere Give-aways. Ob Feuerzeug, LED-Taschenlampe oder Kugelschreiber – hier ist garantiert für jeden was dabei. Und das besonders günstig im attraktiven Paketpreis, natürlich inklusive Bedruckung. Inkl. aller Druck- und Vorkosten für Standardschriften, Mehrpreiseinfarbig.fürLogo/Sonderschriften 13,194 947 silber 149,194 955 schwarz 149,175TEILE149 .-














































































* Komplettpreis inklusiv einseitigen einfarbigen Werbedruck in Standardschrift auf alle Teile, Logo/Sonderschrift zzgl. 13,-. fürGRATISSiedazu:Trolleykoffer 99WERBESETS | 1 WERBESET*, 1001 TEILE INKL. TROLLEYKOFFER • 200 Feuerzeuge, transparent blau • 200 Feuerzeuge, transparent rot • 50 Piezo-Feuerzeuge, blau/schwarz • 50 Piezo-Feuerzeuge, weiß • 200 Kugelschreiber, blau/weiß • 200 Kugelschreiber, grün/weiß • 50 Big-Pen weiß/schwarz • 50 Big-Pen rot/schwarz • 1 1.000Trolleykofferüberzeugende Werbeträger, fix und fertig mit Ihrem Werbedruck versehen, in einem praktisch-schönen Koffer. Trolley-Koffer: Mit Teleskopgriff. Große Reißverschlussfächer auf Vorder- und Rückseite, kleines Utensilienfach vorn. Maße: 55 x 34 x 29 cm. Griff ausgezogen 104 cm Hinweis: inkl. aller Druck- und Vorkosten für Standar dschriften, einfarbig. Mehrpreis für Logo/Sonderschriften 13,105 999 399,2 „SWING“KUGELSCHREIBER/„SWAY“, 400 STK. Ein silberfarbenes Kunststoffgehäuse für den „Swing“ oder vollfarbenes für den „Sway“ mit einer farbigen Griffmanschette kennzeichnen diese markante Schreibgeräte. Dazu ein verchromter Metallklipp sowie ein silberfarbener Drücker und Spitze. Blauschreibende Kunststoff-Großraummine. Einzelartikel siehe Seite 113. Logo/Sonderschrift zzgl. 13,116 833 silber/blau 179,116 841 silber/rot 179,161 826 weiß 179,161 834 blau 179,1001TEILE399 .400TEILE179 .-






































































































































































IMMER GRIFFBEREIT Lieferung nur für den gewerblichen Bedarf. Alle Preise zzgl. MwSt.100 | WERBESETS 4 STABILA QUALITÄTS-ZOLLSTOCK, 2 M, 45 STK. Der Zollstock der den Maßstab setzt. Natürlich von Stabila mit neuem patentierten Federgelenk. Das verwendete Buchenholz stammt aus nachhaltig bewirtschafteten Wäldern. Ein Qualitätsprodukt „Made in EU“. Einzelartikel siehe Seite 163. 151 664 weiß 195,151 672 gelb 195,19545TEILE.250TEILE115 .300TEILE109 .100TEILE129 .3 EINWEG-GASFEUERZEUGE, MIT REIBRADZÜNDUNG, 300 STK Flammenhöhe verstellbar. Der Preis beinhaltet den einseitigen einfarbigen Werbedruck in Logo/SonderschriftStandardschrift zzgl. 13,Werbefl äche: 50 x 13 mm Einzelartikel siehe Seite 130. 093 799 blau 109,093 774 weiß 109,2 PARKSCHEIBEN, 250 STK. Aus Altpapier hergestellt und mit dem Umweltengel ausgezeichnet. Rückseite mit Reiserechner. Der Preis beinhaltet den einseitigen einfarbigen Werbedruck in Standardschrift auf alle Teile, Logo/Sonderschrift zzgl. 13,Werbefl äche: 80 x 25 mm Einzelartikel siehe Seite 182. 101 489 115,1 REFLEX CLACK-BÄNDER, 100 STK. Ein „Muss“ für alle, die im Straßenverkehr unterwegs sind: Reflektierende Armbänder aus Kunststoff. Einzelartikel siehe Seite 158. 136 083 158,-














































































WERBESETS SIND IDEAL FÜR MESSEN, MEETINGS ODER ALS MINI TOBOTSCHAFTWERBE-GO... * Komplettpreis inklusiv einseitigen einfarbigen Werbedruck in Standardschrift auf alle Teile, Logo/Sonderschrift zzgl. 13,-. 1 160 HAFTNOTIZ-SETS 160 Briefchen aus silberfarbenem Karton, Inhalt je 5 neonfarbene Haftnotizblöckchen. W Werbedruck. Fläche: 60 x 25 mm Logo/Sonderschrift zzgl. 13,101 456 99,101WERBESETS | 2 200 SCHREIBER„FUN TOUCH“ Drehkugelschreiber und Touch-Pen in formschöner Kombination aus Kunststoff. Spitze, mittlerer und oberer Ring sind aus verchromtem Kunststoff, der Clip ist aus verchromtem Stahl. Blauschreibende Qualitätsmine. W Werbedruck. Fläche: 40 x 7 mm Logo/Sonderschrift zzgl. 13,Einzelartikel siehe Seite 119 184 058 blau 129,184 066 rot 129,3 150 „COLORADO“BAMBUS-SCHREIBER Dank seines Schaftes aus Bambus überzeugt dieser Kugelschreiber nicht nur in ökologischer, sondern auch in stilistischer Hinsicht. Mit Metall-Clip und blauschreibender Mine. W Werbedruck. Fläche: 50 x12 mm Logo/Sonderschrift zzgl. 13,Einzelartikel siehe Seite 41. 187 257 159,160TEILE99 .200TEILE129 .150TEILE159 .-
































































































































SENATOR „CHALLENGERKUGELSCHREIBERBASIC“ Druckkugelschreiber, hochglänzendes weißes Gehäuse und formschön geschwungener Clip in 5 attraktiven Farben. Ausgestattet mit der senator ® magic flow Mine, 1.0 mm für ein herausragend angenehmes Schreibgefühl. Blauschreibende QualitätsGroßraummine D Digitaldruck 4c mit 3D-Effekt.
Fläche: Schaft: 70 x 35 mm. Preis/Stk.: ab 500 Stück -,28 Einmalige Werkzeugkosten: 55,162 739 weiß/blau ab -,39 162 747 weiß/rot ab -,39 162 755 weiß/orange ab -,39 162 763 weiß/grün ab -,39 162 771 weiß/gelb ab -,39 1 SENATOR KUGELSCHREIBER „LIBERTY BASIC“ ab 0 33 STÜCKAB STÜCK-PREIS 1.SCHAFTFARBE 1.KLIPPFARBE DIGITAL4C 10.0005.0002.5001.0005001-,65–-,59-,13-,15-,28-,55-,12-,14-,23-,52-,11-,13-,19-,45-,09-,12-,17-,39-,08-,11-,15DruckkostenweitereFarben:sieheOnlineshop STÜCKAB STÜCK-PREIS 1.SCHAFTFARBE 1.KLIPPFARBE DIGITAL4C 10.0005.0003.0001.0005001-,49–-,45-,13-,15-,28-,43-,12-,14-,23-,39-,11-,13-,19-,35-,10-,12-,17-,33-,09-,11-,15DruckkostenweitereFarben:sieheOnlineshop 2 SENATOR „CHALLENGERKUGELSCHREIBERBASIC“ ab 0 39
2
162
Druck 3d-Effektmit Lieferung nur für den gewerblichen Bedarf. Alle Preise zzgl. MwSt.102 | HD-RELIEFSCHREIBER DRUCK 3D-EFFEKTMIT 1
SENATOR KUGELSCHREIBER „LIBERTY BASIC“ Hochwertiger Design-Druckkugelschreiber, hochglänzendes weißes Gehäuse mit geradlinig verlaufendem Clip. Transparenter Ring am Oberteil in 5 attraktiven Farben. Ausgestattet mit der senator ® magic flow Mine, 1.0 mm für ein perfektes Schreibgefühl. Blauschreibende Qualitäts-Großraummine. D Digitaldruck 4c mit 3D-Effekt. Fläche: Schaft: 70 x 33 mm. Preis/Stk.: ab 500 Stück -,28 Einmalige Werkzeugkosten: 55,162 683 weiß/blau ab -,33 162 691 weiß/rot ab -,33 162 706 weiß/orange ab -,33 162 714 weiß/grün ab -,33 722 weiß/schwarz ab -,33



































103SCHREIBER | ABBAUBARBIOLOGISCH 1 SENATOR SCHREIBER „NATURE PLUS“ Nachhaltiger Werbeerfolg, der zugleich die Umwelt schont. Das Gehäuse dieses Druckkugelschreibers ist aus biologisch abbaubarem Material, hat eine langlebige senator ® magic flow G2 Mine und wird selbstverständlich in Deutschland produziert. S Siebdruck. Fläche: in Verlängung vom Klipp 35 x 20 mm Preis/Stk.: ab 200 Stück -,14 W Werbedruck. Fläche: auf Klipp: 30 x 5 mm Preis/Stk.: ab 200 Stück -,14 Werkzeugkosten: Siehe Serviceseiten. D Digitaldruck 4c. Fläche: 40 x 6 Preis/Stk.:mm ab 200 Stück -,30 Datenhandling: einmalig 29,181 076 blau ab -,59 181 084 weiß ab -,59 181 092 grün ab -,59 181 105 rot ab -,59 181 113 dunkelgrau ab -,59 181 121 hellgrau ab -,59 1 SENATOR SCHREIBER „NATURE PLUS“ ab 0 59 STÜCKAB STÜCK-PREIS 1.DRUCKFARBE DIGITAL4C Druckkosten5.0003.0001.000-,79-,10-,205002001-,99–-,89-,14-,30-,85-,11-,24-,69-,09-,18-,59-,08-,16weitereFarben:sieheOnlineshop 2 SENATOR SCHREIBERDRUCKKUGEL-„SUPERHITICY“ In transparentem Frosty-Gehäuse und kompaktem, großflächigem Klipp. Schwarzschreibende DIN-Mine S Siebdruck. Fläche: in Verlängung vom Klipp: 50 x 20 mm W Werbedruck. Fläche: Klipp: 35 x 6 mm Preis/Stk.: ab 400 Stück -,15 Werkzeugkosten: Siehe Serviceseiten. 137 553 blau ab -,23 137 561 grün ab -,23 137 570 orange ab -,23 082 600 rot ab -,23 082 618 gelb ab -,23 2 SENATOR „SUPERKUGELSCHREIBERDRUCK-HITICY“ ab 0 23 STÜCKAB STÜCK-PREIS 1.DRUCKFARBE 1 -,40 400 -,32 -,15 1.000 -,30 -,14 2.500 -,28 -,13 5.000 -,25 -,12 10.000 -,23 -,10 Druckkosten weitere Farben: siehe Onlineshop * Komplettpreis inklusiv einfarbigem, einseitigen Werbeaufdruck in Standardschrift 500 064064064„SUPERDRUCKKUGELSCHREIBERHITICY“171blau251grün260orange 259.-WERBETIPP* DRUCK4C MADE GERMANYIN


































































250 SENATOR 013SOFTSCHREIBER„HATTRIX®DRUCKKUGEL-CLEAR“448blau 249.-WERBETIPP* Lieferung nur für den gewerblichen Bedarf. Alle Preise zzgl. MwSt.104 | SCHREIBER 1 SENATOR KUGELSCHREIBER „SUPER HIT BIO MATT“ Ein umweltbewusster Botschafter für Ihre Marke: Den blauschreibenden Klassiker von Senator gibt es jetzt auch aus innovativem Bio-Kunststoff. Hergestellt aus nachwachsenden Rohstoffen, langlebig und biologisch abbaubar. S Siebdruck. Fläche: auf den Schaft 50 x 20 mm W Werbedruck. Fläche: auf den Klipp 35 x 6 mm Preis/Stk.: ab 500 Stück -,15 Werkzeugkosten: Siehe Serviceseiten. 190 817 weiß ab -,29 190 825 gelb ab -,29 190 833 orange ab -,29 190 841 rot ab -,29 190 850 hellblau ab -,29 190 868 dunkelblau ab -,29 190 876 hellgrün ab -,29 190 884 dunkelgrün ab -,29 190 892 hellgrau ab -,29 190 905 dunkelgrau ab -,29 197 011 schwarz ab -,29 STÜCKAB STÜCK-PREIS 1.DRUCKFARBE 1 -,47 500 -,42 -,15 1.000 -,37 -,14 2.500 -,35 -,13 5.000 -,32 -,12 10.000 -,29 -,10 Druckkosten weitere Farben: siehe Onlineshop 1 SENATOR KUGELSCHREIBER „SUPER HIT BIO MATT“ ab 0 29 2 SENATOR SOFTSCHREIBER„HATTRIX®DRUCKKUGEL-CLEAR“ Hochwertiger Kugelschreiber mit Kappendruck-Mechanik. Mit ergonomischen Profilrinnen zum sicheren Halt. Großer geschwungener Klipp. Blauschreibend. Große Werbefläche auf dem transparentfarbenen Gehäuse. S Siebdruck. Fläche: Schaft: 40 x 20 mm Preis/Stk.: ab 200 Stück -,18 Werkzeugkosten: Siehe Serviceseiten. 011 949 rot ab -,49 012 007 gelb ab -,49 011 836 blau ab -,49 STÜCKAB STÜCK-PREIS 1.DRUCKFARBE 1 -,79 200 -,72 -,18 1.000 -,69 -,16 2.500 -,59 -,15 5.000 -,49 -,12 Druckkosten weitere Farben: siehe Onlineshop 2 „HATTRIX®DRUCKKUGELSCHREIBERSENATORSOFTCLEAR“ ab 0 49 BIOBASEDMADE GERMANYIN




















































farbiger Akzent 105SCHREIBER | 2 SENATOR SCHREIBERDRUCKKUGEL-„POINT“ Die perfekte Wahl für alle, die den Akzent auf ihren Unternehmensnamen oder ihr Firmenlogo legen wollen. Spitze, Klipp und Drücker aus Metall. Blauschreibende Qualitätsmine. S Siebdruck. Fläche: Schaft: 35 x 12 mm Preis/Stk.: ab 300 Stück -,15 Werkzeugkosten: Siehe Serviceseiten. 165 160 weiß ab -,29 165 178 schwarz ab -,29 165 186 blau ab -,29 165 194 rot ab -,29 166 244 gelb ab -,29 2 SENATOR SCHREIBERDRUCKKUGEL-„POINT“ ab 0 29 STÜCKAB STÜCK-PREIS 1.DRUCKFARBE 1 -,55 300 -,49 -,15 1.000 -,42 -,14 3.000 -,39 -,12 5.000 -,35 -,10 10.000 -,29 -,09 Druckkosten weitere Farben: siehe Onlineshop 1 SENATOR SOFTSCHREIBERDRUCKKUGEL-„CHALLENGER“CLEAR Druckkugelschreiber mit ergonomischer Griffzone. Transparentes Gehäuse. Breiter, doppelt geschwungener Kunststoff-Super-Großraummine.Klipp.Blauschreibend. Große Werbefläche. S Siebdruck. Fläche: Schaft: 35 x 12 mm W Werbedruck. Fläche: Klipp: 35 x 7 mm Preis/Stk.: ab 200 Stück -,18 Werkzeugkosten: Siehe Serviceseiten. 273 593 rot ab -,45 271 684 blau ab -,45 271 692 orange ab -,45 271 705 gelb ab -,45 271 713 grün ab -,45 1 DRUCKKUGELSCHREIBERSENATOR„CHALLENGER“SOFTCLEAR ab 0 45 STÜCKAB STÜCK-PREIS 1.DRUCKFARBE 1 -,82 200 -,75 -,18 1.000-,72 -,16 2.500 -,68 -,15 5.000-,59 -,12 10.000 -,49 -,11 20.000-,45 -,09 Druckkosten weitere Farben: siehe Onlineshop * Komplettpreis inklusiv einfarbigem, einseitigen Werbeaufdruck in Standardschrift

















Lieferung nur für den gewerblichen Bedarf. Alle Preise zzgl. MwSt.106 | SCHREIBER 1 SENATOR ELEGANZSCHREIBERDRUCKKUGEL-„SOFTSPRING“ Hochwertiges Schreibgerät mit silberfarbiger Kunststofffeder als Drücker. Ein dezenter Metall-Klipp, ein elegantes Gehäuse und die ergonomisch geformte Kunststoffmanschette runden den idealen Werbeträger ab. Mit blauschreibender Super-Großraum-Mine. S Siebdruck. Fläche: Schaft in Verlängerung des Klipps, 30 x 20 mm. Oder seitlich vom Klipp, 50 x 15 mm Preis/Stk.: ab 100 Stück -,29 Werkzeugkosten: Siehe Serviceseiten. 274 754 blau ab -,99 274 762 rot ab -,99 274 779 silber ab -,99 286 723 weiß ab -,99 082 626 schwarz ab -,99 2 SENATOR METALLSCHREIBER,DRUCKKUGEL-„NEWSPRING“ Extravaganter Druckkugelschreiber mit origineller Kunststoff-Großraummine.tallisierteGlanzvernickelterKappendruck-Mechanik.Metall-Klippundme-Innenhülse.Blauschreibende S Siebdruck. Fläche: Schaft: 40 x 20 mm Preis/Stk.: ab 150 Stück -,19 Werkzeugkosten: Siehe Serviceseiten. 274 711 trans. blau ab -,84 274 720 trans. rot ab -,84 274 738 trans. grün ab -,84 166 687 schwarz ab -,84 160 608 weiß ab -,84 1 SENATOR DRUCKKUGELSCHREIBER „SOFT SPRING“ ab 0 99 STÜCKAB STÜCK-PREIS 1.DRUCKFARBE 1 1,49 100 1,39 -,29 5001,29 -,18 1.000 1,19 -,17 2.5001,09 -,16 5.000 -,99 -,14 Druckkosten weitere Farben: siehe Onlineshop STÜCKAB STÜCK-PREIS 1.DRUCKFARBE 15011,291,19 -,19 5001,09 -,18 1.000 -,99 -,17 3.000-,84 -,15 Druckkosten weitere Farben: siehe Onlineshop 2 SENATOR DRUCKKUGELSCHREIBER „NEW SPRING“ METALL ab 0 84 MADE GERMANYIN


























200 281010„BIGSCHREIBERDRUCKKUGEL-PEN“825weiß/schwarz333weiß/blau 209.-WERBETIPP* 107SCHREIBER | 2 SENATOR „CHALLENKUGELSCHREIBERGERICY“ Druckkugelschreiber mit matt transparentem Gehäuse. Breiter, doppelt geschwungener Klipp. Markanter Oberteilabschluss. Qualitäts-Großraummine.Blauschreibende S Siebdruck. Fläche: Schaft: 50 x 20 mm W Werbedruck. Fläche: Klipp: 35 x 7 mm Preis/Stk.: ab 250 Stück -,18 Werkzeugkosten: Siehe Serviceseiten. 111 110 blau ab -,39 111 128 rot ab -,39 111 136 weiß ab -,39 111 152 grün ab -,39 STÜCKAB STÜCK-PREIS 1.DRUCKFARBE 1 -,65 250 -,59 -,18 1.500 -,53 -,16 3.000 -,49 -,15 10.000 -,39 -,14 Druckkosten weitere Farben: siehe Onlineshop 2 SENATOR „CHALLENGERDRUCKKUGELSCHREIBERICY“ ab 0 39 1 SENATOR SCHREIBERKUGEL„ BIG-PEN“ ab 0 45 1 SENATOR SCHREIBERDRUCKKUGEL-„BIG-PEN“ Das Jumbo-Gehäuse mit breiter Gummi-Manschette liegt griffig in der Hand. Drücker mit abrutschsicherem Profil, markanter U-Boot-Klipp. Schwarzschreibend. Made in Germany. S Siebdruck. Fläche: 50 x 15 mm Preis/Stk.: ab 200 Stück -,18 Werkzeugkosten: Siehe Serviceseiten. 011 447 weiß/schw. ab -,45 011 455 rot/schw. ab -,45 011 463 blau/schw. ab -,45 011 471 gelb/schw. ab -,45 011 498 gelb/bunt ab -,45 066 021 weiß/grau ab -,45 274 826 weiß/blau ab -,45 STÜCKAB STÜCK-PREIS 1.DRUCKFARBE 1 -,85 200 -,75 -,18 1.000-,65 -,16 2.500 -,55 -,14 5.000-,49 -,13 10.000 -,45 -,12 Druckkosten weitere Farben: siehe Onlineshop












































Druckkosten weitere
Der komplett gummierte, zweifarbige Schaft macht diesen schwarzschreibenden Kugelschreiber zu einem besonderen Hingucker. -,30 -,16 1.000 -,29 -,15 2.500 -,26 -,14 5.000 -,23 -,13 10.000 -,19 -,12 Farben: siehe Onlineshop lange silberfarbene Schaft mit dem Metallklipp prägt dieses moderne Schreibgerät. Das Oberteil ist transparentfarbig abgesetzt.
Der geschwungene Clip mit farbiger Einlage macht diesen Kunststoffkugelschreiber zu einem schwarzschreibend.MitaufmerksamkeitsstarkenbesondersWerbeträger.GroßraummineausKunststoff, W Werbedruck. Fläche: auf Schaft, 40 x 7 mm oder auf Klipp, 30 x 5 mm Preis/Stk.: ab 400 Stück -,16 D Digitaldruck 4c. Fläche: auf Schaft, 40 x 7 mm Preis/Stk.: ab 400 Stück -,32 Werkzeugkosten: Siehe Serviceseiten. 803 blau ab -,21 173 811 rot ab -,21 173 820 grün ab -,21 838 gelb ab -,21 STÜCKAB STÜCK-PREIS 1.DRUCKFARBE DIGITAL4C 1 -,32 400 -,28 -,16 -,32 1.000 -,27 -,15 -,30 2.000 -,25 -,13 -,28 5.000 -,23 -,11 -,24 10.000 -,21 -,09-,22 Druckkosten weitere Farben: siehe Onlineshop
DRUCK4C 1 KUGELSCHREIBER POLYSILVER METALLKLIPP „MEXICO“ Der
3 „MODERNKUGELSCHREIBERRUBBER“
farbigemEinsatz Lieferung nur für den gewerblichen Bedarf. Alle Preise zzgl. MwSt.108 | SCHREIBER 2 „MERAN“DREHKUGELSCHREIBER
Schwarzschreibende Qualitätsmine. W Werbedruck. Fläche: 40 x 7 mm. Preis/Stk.: ab 400 Stück -,16 Werkzeugkosten: Siehe Serviceseiten. 173 926 violet ab -,19 173 934 grün ab -,19 3 „MODERNKUGELSCHREIBERRUBBER“ ab 0 19 STÜCKAB STÜCK-PREIS 1.DRUCKFARBE 1 -,35 400
2 DREHKUGELSCHREIBER „MERAN“ ab 0 21
173
Drücker in silber mit farbigem Einsatz. Blauschreibende Qualitätsmine. S Siebdruck. Fläche: auf dem Schaft 50 x 14 mm Preis/Stk.: ab 500 Stück -,14 Werkzeugkosten: Siehe Serviceseiten. 290 631 blau ab -,15 290 658 schwarz ab -,15 290 640 rot ab -,15 STÜCKAB STÜCK-PREIS 1.DRUCKFARBE 1 -,34 500 -,25 -,14 1.500 -,22 -,12 5.000 -,19 -,11 10.000 -,17 -,10 20.000 -,15 -,09 Druckkosten weitere Farben: siehe Onlineshop 1 „MEXICO“KUGELSCHREIBER ab 0 15
173















































1 KUGELSCHREIBER „PLAIN“ Dieser schwarzschreibende Kugelschreiber aus Kunststoff hat einen Druckmechanismus und ist in sieben leuchtenden Farben erhältlich. S Fläche:Siebdruck. 55 x 12 mm auf Schaft Preis/Stk.: ab 1.000 Stück -,12 Werkzeugkosten: Siehe Serviceseiten. 207 083 weiß ab -,08 207 075 schwarz ab -,08 207 091 blau ab -,08 207 106 rot ab -,08 207 114 grün ab -,08 207 122 orange ab -,08 207 139 gelb ab -,08 STÜCKAB STÜCK-PREIS 1.DRUCKFARBE 1 -,18 1.000 -,15 -,12 2.500 -,14 -,11 5.000 -,13 -,10 10.000 -,12 -,09 20.000 -,10 -,08 30.000 -,08 -,07 Druckkosten weitere Farben: siehe Onlineshop 1 „PLAIN“KUGELSCHREIBER ab 0 08 150 093„CHICAGO“KUGELSCHREIBER942blau 179.-WERBETIPP* 1.000 225„PLAIN“KUGELSCHREIBER867weiß 289.-WERBETIPP* 109SCHREIBER | 2 „CHICAGO“METALL-KUGELSCHREIBER Das schlanke Metall-Oberteil und die dicke, gummiähnliche, weiche Griffzone kennzeichnen dieses farbenfrohe Schreibgerät. Silberfarbene Metallspitze, Klipp und Drücker. Kunststoff-Großraummine.Blauschreibende Ä Ätzung. Fläche: ca. 35 x 5 mm Preis/Stk.: ab 200 Stück -,38 W Werbedruck. Fläche: ca. 35 x 7 Preis/Stk.:mmab200 Stück -,36 Werkzeugkosten: Siehe Serviceseiten. 287 050 blau ab -,39 287 076 grün ab -,39 287 084 orange ab -,39 2 „CHICAGO“METALL-KUGELSCHREIBER ab 0 39 STÜCKAB STÜCK-PREIS 1.DRUCKFARBE ÄTZUNG 1 -,74 200 -,67 -,36 -,38 400 -,65-,33-,34 1.000 -,62-,28 -,29 2.500 -,56-,27-,27 5.000 -,49 -,26 -,26 10.000 -,39-,22-,22 Druckkosten weitere Farben: siehe Onlineshop * Komplettpreis inklusiv einfarbigem, einseitigen Werbeaufdruck in Standardschrift





























































„TWISTERDREHKUGELSCHREIBERFROZEN“
Moderner Kugelschreiber aus deutscher Produktion mit bedienerfreundlicher Drehmechanik. -,09 -,35 -,12
Drehmechanik GROSSE GARANTIERENWERBEFLÄCHESTÄRKSTE AUFMERKSAMKEIT Lieferung nur für den gewerblichen Bedarf. Alle Preise zzgl. MwSt.110 | SCHREIBER 2 „TWISTERDREHKUGELSCHREIBERFROZEN“ ab 0 24 1 „GLITZER“DRUCKKUGELSCHREIBER Eleganter Schreiber in „Jewel-Optik“. Metall-Klipp verchromt, Drücker und Unterteil aus silberfarbenem Kunststoff. Griffleiste aus Metall in Lochoptik. Blauschreibende Qualitätsmine. W Werbedruck. Fläche: auf Gehäuse, 40 x 12 mm Preis/Stk.: ab 400 Stück -,20 Werkzeugkosten: Siehe Serviceseiten. 123 638 türkis ab -,26 123 646 pink ab -,26 105 134 schwarz ab -,26 105 142 blau ab -,26 105 159 rot ab -,26 105 167 silber ab -,26 105 175 orange ab -,26 STÜCKAB STÜCK-PREIS 1.DRUCKFARBE 1 -,39 400 -,34 -,20 1.000 -,32 -,17 2.500 -,30 -,14 5.000 -,29 -,12 10.000 -,26 -,11 Druckkosten weitere Farben: siehe Onlineshop 1 DRUCKKUGELSCHREIBER„GLITZER“ ab 0 26 2
2.000
Trendige Frozen-Optik. Große Werbeflächen auf Klipp und Schaft. Deutsche Qualitätsmine. S Siebdruck. Fläche: auf Schaft, 45 x 20 mm W Werbedruck. Fläche: auf Klipp 30 x 4 mm Preis/Stk.: ab 400 Stück -,15 Werkzeugkosten: Siehe Serviceseiten. 284 539 blau ab -,24 284 547 rot ab -,24 284 555 gelb ab -,24 284 563 weiß-trans. ab -,24 STÜCKAB STÜCK-PREIS 1.DRUCKFARBE WEITEREFARBE 1 -,45 400 -,42 -,15-,10 1.000 -,38 -,13
-,08 5.000 -,29 -,11 -,07 10.000 -,24 -,10 -,06 Druckkosten weitere Farben: siehe Onlineshop MADE GERMANYIN

































MADE GERMANYIN Federklipp 111SCHREIBER | 2 „GLOSSY“DREHKUGELSCHREIBER Dieser elegante Dreh-Kugelschreiber verfügt über einen hochglänzenden Metall-Clip und eine Metall-Spitze. Blauschreibende Kunststoff-Großraummine. S Siebdruck. Fläche: auf Schaft, 45 x 20 Preis/Stk.:mmab 150 Stück -,20 L Lasergravur. Fläche: auf Klipp, 20 x 5 Preis/Stk.:mm ab 150 Stück -,25 Werkzeugkosten: Siehe Serviceseiten. 124 315 schwarz ab -,55 124 323 weiß ab -,55 124 331 blau ab -,55 124 340 rot ab -,55 2 „GLOSSY“KUGELSCHREIBER ab 0 55 STÜCKAB STÜCK-PREIS 1.DRUCKFARBE GRAVURLASER1 -,85 150 -,80-,20-,25 300 -,75 -,16 -,24 1.000 -,65 -,15 -,23 2.000 -,62 -,13 -,20 5.000 -,59 -,11 -,18 10.000 -,55 -,10-,16 Druckkosten weitere Farben: siehe Onlineshop 1 „TOPDREHKUGELSCHREIBERSPINSILVER“ Kugelschreiber mit Drehmechanik in Frozen-Optik, silber lackierte Spitze. Qualitäts-Blauschreibende Großraummine. Der Bestseller vom deutschen Hersteller Ritter-Pen verfügt über 2 große Druckflächen auf Schaft und Klipp. W Werbedruck. Fläche: Schaft: 45 x 20 mm. Klipp: 30 x 7 mm Preis/Stk.: ab 500 Stück -,15 Werkzeugkosten: Siehe Serviceseiten. 080 333 blau frosty ab -,18 080 341 rot frosty ab -,18 080 350 grün frosty ab -,18 080 368 frostyorange ab -,18 STÜCKAB STÜCK-PREIS 1.DRUCKFARBE 1 -,34 500 -,28 -,15 2.500 -,26 -,14 5.000 -,24 -,13 10.000 -,22 -,12 20.000 -,18 -,10 Druckkosten weitere Farben: siehe Onlineshop 1 „TOPDREHKUGELSCHREIBERSPINSILVER“ ab 0 18 3 „SPRING“DRUCKKUGELSCHREIBER Der Federklipp zeigt mit seiner farbigen Spitze direkt auf Ihren Werbeaufdruck. Metall-Griffprofil, KunststoffGehäuse. Blauschreibende DIN-Mine auswechselbar. S Siebdruck. Fläche: 45 x 12 mm Preis/Stk.: ab 150 Stück -,18 Werkzeugkosten: Siehe Serviceseiten. 044 671 weiß/blau ab -,59 044 680 weiß/rot ab -,59 3 „SPRING“DRUCKKUGELSCHREIBER ab 0 59 STÜCKAB STÜCK-PREIS 1.DRUCKFARBE 1 -,95 150 -,85 -,18 300 -,80 -,16 1.000 -,75 -,13 5.000 -,65 -,11 10.000 -,59 -,09 Druckkosten weitere Farben: siehe Onlineshop 200 010„SPRING“SCHREIBERDRUCKKUGEL-921blau 229.-WERBETIPP* * Komplettpreis inklusiv einfarbigem, einseitigen Werbeaufdruck in Standardschrift








































DRUCK4C BRINGEN SIE FARBE INS SPIEL ! MEGA-SELLER IN TOLLEN KOMBINATIONENLieferungnurfürden gewerblichen Bedarf. Alle Preise zzgl. MwSt.112 | SCHREIBER 2 „SWAYKUGELSCHREIBERBLACK“ Die taillierte Schaftform macht diesen zweifarbigen Kugelschreiber aus Kunststoff zu einem besonders beliebten Schreibgerät. Blauschreibend mit Großraummine, der Clip und die Spitze sind aus Metall. Griffzone schwarz W Werbedruck. Fläche: 40 x 7 mm Preis/Stk.: ab 400 Stück -,17 Werkzeugkosten: Siehe Serviceseiten. D Digitaldruck 4c. Fläche: 40 x 7 Preis/Stk.:mm ab 400 Stück -,30 Datenhandling: einmalig 29,188 081 schwarz ab -,15 188 090 weiß ab -,15 188 104 blau ab -,15 188 112 rot ab -,15 188 129 apfelgrün ab -,15 188 137 orange ab -,15 STÜCKDRUCK4CAB STÜCK-PREIS 1.DRUCKFARBE DIGITAL4C Druckkosten10.0005.000-,192.5001.000-,244001-,29–-,26-,17-,30-,14-,28-,20-,13-,26-,11-,22-,15-,10-,20weitereFarben:sieheOnlineshop 2 „SWAYKUGELSCHREIBERBLACK“ ab 0 15 1 „WHITEKUGELSCHREIBERSWAY“ Der Klassiker Nummer 1! Die stylish farbige Griffmanschette kennzeichnet dieses markante Schreibgerät. Dazu ein verchromter Metallklipp sowie ein silberner Drücker und Spitze. Blauschreibende Kunststoff-Großraummine. W Werbedruck. Fläche: 40 x 7 mm Preis/Stk.: ab 400 Stück -,17 Werkzeugkosten: Siehe Serviceseiten. D Digitaldruck 4c. Fläche: 40 x 7 Preis/Stk.:mm ab 400 Stück -,30 Datenhandling: einmalig 29,150 594 dunkelblau ab -,15 150 609 rot ab -,15 150 617 grün ab -,15 150 625 orange ab -,15 1 „WHITEKUGELSCHREIBERSWAY“ ab 0 15 Preistabelle für Pos. 1 und 2





































WWW.IHR-LOGO.BIZDRUCK4CDRUCK4C 113SCHREIBER |* Komplettpreis inklusiv einfarbigem, einseitigen Werbeaufdruck in Standardschrift 2 „SWAY“KUGELSCHREIBER Der Klassiker in modisch eleganten Farben. Oberteil transparenter Kunststoff, Unterteil mit farbiger Griffmanschette. Der Klipp ist aus verchromtem Metall. Spitze, Ring und Drücker sind aus silbernem Kunststoff. Kunststoff-Großraummine.Blauschreibende W Werbedruck. Fläche: 40 x 7 mm Preis/Stk.: ab 400 Stück -,17 Werkzeugkosten: Siehe Serviceseiten. D Digitaldruck 4c. Fläche: 40 x 7 Preis/Stk.:mm ab 400 Stück -,30 Datenhandling: einmalig 29,124 606 magenta ab -,15 123 978 schwarz ab -,15 123 986 weiß ab -,15 123 994 gelb ab -,15 110 561 blau ab -,15 110 570 rot ab -,15 110 588 orange ab -,15 110 596 grün ab -,15 1 „SWING“KUGELSCHREIBER Der Klassiker Nummer 1! Die stylish farbige Griffmanschette kennzeichnen dieses markante Schreibgerät. Dazu eine verchromter Metallklipp sowie ein silberner Drücker und Spitze. Blauschreibende Kunststoff-Großraummine. W Werbedruck. Fläche: 40 x 7 mm Preis/Stk.: ab 400 Stück -,17 Werkzeugkosten: Siehe Serviceseiten. D Digitaldruck 4c. Fläche: 40 x 7 Preis/Stk.:mm ab 400 Stück -,30 Datenhandling: einmalig 29,124 001 schwarz ab -,15 090 312 rot ab -,15 090 337 orange ab -,15 090 329 grün ab -,15 090 304 blau ab -,15 2 „SWAY“KUGELSCHREIBER ab 0 15 1 „SWING“KUGELSCHREIBER ab 0 15 STÜCKAB STÜCK-PREIS 1.DRUCKFARBE DIGITAL4C 1 -,27 400 -,25 -,17 -,30 1.000 -,23 -,14 -,28 2.500 -,20 -,13 -,26 5.000 -,18 -,11 -,22 10.000 -,15-,10 -,20 Druckkosten weitere Farben: siehe Onlineshop STÜCKAB STÜCK-PREIS 1.DRUCKFARBE DIGITAL4C 1 -,27 400 -,25 -,17 -,30 1.000 -,23 -,14 -,28 2.500 -,20 -,13 -,26 5.000 -,18 -,11 -,22 10.000 -,15-,10 -,20 Druckkosten weitere Farben: siehe Onlineshop 400 116116„SWING“KUGELSCHREIBER833blau841rot 195.-WERBETIPP* 400 161161„SWAY“KUGELSCHREIBER826weiß834blau 195.-WERBETIPP*





























WERBEKUGELSCHREIBER MIT TOUCH! SCHREIBEN MIT ANGENEHMER HAPTIKLieferung nur für den gewerblichen Bedarf. Alle Preise zzgl. MwSt.114 | SCHREIBER 2 SCHREIBER „TUNIS“ ab0 22 2 SCHREIBER „TUNIS“ Dieser Kugelschreiber aus Kunststoff liegt dank Softtouch-Oberfläche nicht nur besonders gut in der Hand, sondern fällt mit seinem besonderen Muster im Griffbereich auch ins Auge. Mit schwarzem Clip und blauschreibender X-20 Mine. W Werbedruck. Fläche: 45 x 7 mm, seitllich vom Klipp Preis/Stk.: ab 400 Stück -,16 Werkzeugkosten: Siehe Serviceseiten. 197 693 dunkelblau ab -,22 197 708 rot ab -,22 197 716 gelb ab -,22 197 724 hellblau ab -,22 197 732 grün ab -,22 197 749 orange ab -,22 STÜCKAB STÜCK-PREIS 1.DRUCKFARBE 1 -,38 400 -,34 -,16 1.000 -,32 -,15 2.500 -,29 -,14 5.000 -,26 -,13 10.000 -,22 -,10 Druckkosten weitere Farben: siehe Onlineshop 1 SCHREIBER „GRAN CANARIA“ Äußert raffiniert wiederholt sich bei diesem schwarzen Kunststoffkugelschreiber mit matter Softtouch-Oberfläche die Farbe des Clips zugleich im innovativen Muster des Griffbereichs. Mit blauschreibender X-20 Mine. W Werbedruck. Fläche: 45 x 7 mm seitlich vom Klipp Preis/Stk.: ab 400 Stück -,16 Werkzeugkosten: Siehe Serviceseiten. 197 757 dunkelblau ab -,22 197 765 rot ab -,22 197 790 hellblau ab -,22 197 773 orange ab -,22 197 781 gelb ab -,22 197 804 grün ab -,22 STÜCKAB STÜCK-PREIS 1.DRUCKFARBE 1 -,38 400 -,34 -,16 1.000 -,32 -,15 2.500 -,29 -,14 5.000 -,26 -,12 10.000 -,22 -,10 Druckkosten weitere Farben: siehe Onlineshop 1 „GRANSCHREIBERCANARIA“ ab 0 22

















































































1 DREHKUGELSCHREIBER„DS3“ ab 0 59 115SCHREIBER | 2 „RAPID“DRUCKKUGELSCHREIBER Preisgünstiger Druckkugelschreiber in Standardform. Geriffeltes Griffprofil, breiter Klipp, wechselbarBlauschreibendeKunststoffgehäuse.Garantiemine,ausW Werbedruck. Fläche: Schaft: 50 x 11 mm. Klipp: 32 x 4 mm Preis/Stk.: ab 800 Stück -,12 Werkzeugkosten: Siehe Serviceseiten. 107 092 (Griffweiß/blaublau) ab -,12 107 113 weiß/rot ab -,12 107 121 weiß/grün ab -,12 107 156 rot/schwarz ab -,12 107 172 gelb/schwarz ab -,12 STÜCKAB STÜCK-PREIS 1.DRUCKFARBE -,22 800 -,18 -,12 2.500 -,15 -,11 5.000 -,14 -,10 10.000 -,12 -,08 Druckkosten weitere Farben: siehe Onlineshop 2 DRUCKKUGELSCHREIBER„RAPID“ 0 12 ab (Griff blau) STÜCK172 2.5008001 1 DREHKUGELSCHREIBER„DS3“ Transparentes Kunststoffgehäuse in leuchtenden „Frosted“-Farben, wahlweise mit satinierter Metallspitze oder mit Kunststoffspitze. Schwarzschreibende Kunststoff-Großraummine. S Siebdruck. Fläche: 45 x 24 mm Preis/Stk.: ab 100 Stück -,23 Werkzeugkosten: Siehe Serviceseiten. Kunststoffspitze 178 202 weiß ab -,59 178 180 rot ab -,59 178 198 anthrazit ab -,59 178 171 blau ab -,59 Satinierte Metallspitze 178 163 weiß ab -,85 217 561 rot ab -,85 141 495 anthrazit ab -,85 217 553 blau ab -,85 STÜCKAB KUNST-STOFF-SPITZE METALL-SATIN.SPITZE 1.DRUCKFARBE 1 -,97 1,19 100 -,94 1,15 -,23 500-,79 1,05 -,19 1.000 -,69 -,95 -,15 3.000 -,59 -,85 -,13 Druckkosten weitere Farben: siehe Onlineshop WEITERE PRODIRSCHREIBER FINDEN SIE IN UNSEREM ONLINESHOP!






































2 KUGELSCHREIBER„SENSATION“ ab 0DIESE29 SCHREIBER LIEGEN ANGENEHM IN DER HAND 1 SCHREIBER „FLORIDA“ ab 0 24 Lieferung nur für den gewerblichen Bedarf. Alle Preise zzgl. MwSt.116 | SCHREIBER 3 „SEATTLE“METALL-KUGELSCHREIBER Matt gebürsteter Edelstahl macht diesen blauschreibenden Kugelschreiber zu einem besonders edlen Schreibgerät. Besonderer Hingucker ist die gelochte Grifffläche. Metallklipp und -spitze. Blauschreibende Qualitätsmine. S Siebdruck. Fläche: auf Schaft: 45 x 10 mm Preis/Stk.: ab 150 Stück -,23 Werkzeugkosten: Siehe Serviceseiten. 160 874 silber ab -,49 160 882 blau ab -,49 160 899 rot ab -,49 3 METALL-KUGELSCHREIBER„SEATTLE“ ab 0 49 STÜCKAB STÜCK-PREIS 1.DRUCKFARBE 1 -,72 150 -,64 -,23 500 -,62 -,22 1.500 -,59 -,20 3.000 -,54 -,18 5.000 -,49 -,16 Druckkosten weitere Farben: siehe Onlineshop 2 KUGELSCHREIBER„SENSATION“ Klippdruck-Kugelschreiber mit Kunststoffgehäuse in Metall-Optik. Dazu 2 markante silberfarbene Metall-Ringe sowie ein Metall-Klipp. KunststoffGroßraummine blauschreibend. W Werbedruck. Fläche: auf Gehäuse, 40 x 10 mm Preis/Stk.: ab 300 Stück -,17 Werkzeugkosten: Siehe Serviceseiten. 103 843 silber ab -,29 103 851 schwarz ab -,29 103 860 blau ab -,29 103 878 rot ab -,29 STÜCKAB STÜCK-PREIS 1.DRUCKFARBE 1 -,44 300 -,39 -,17 600 -,38 -,16 1.500 -,36 -,15 3.000 -,33 -,14 5.000 -,29 -,12 Druckkosten weitere Farben: siehe Onlineshop 1 SCHREIBER „FLORIDA“ Dieser überaus leichte Kunststoffkugelschreiber überzeugt durch seine perfekte, matt gebürstete Metalloptik. Blauschreibende Garantie-Mine. S Siebdruck. Fläche: 35 x 12 mm Preis/Stk.: ab 400 Stück -,14 Werkzeugkosten: Siehe Serviceseiten. 131 573 schwarz ab -,24 164 222 silber ab -,24 164 239 blau ab -,24 164 247 rot ab -,24 164 255 grün ab -,24 STÜCKAB STÜCK-PREIS 1.DRUCKFARBE 1 -,42 400 -,36 -,16 1.000 -,33 -,15 2.500 -,29 -,14 5.000 -,27 -,12 10.000 -,24 -,10 Druckkosten weitere Farben: siehe Onlineshop




























117SCHREIBER | 1 „CREMA“DRUCKKUGELSCHREIBER ab 0 19 1 „CREMA“DRUCKKUGELSCHREIBER Dieser blauschreibende Kugelschreiber liegt super in der Hand. Die bunten Noppen sind nicht nur hübsche Farbtupfer, sondern auch angenehm griffig. S Siebdruck. Fläche: Schaft: 45 x 12 mm Preis/Stk.: ab 400 Stück -,14 Werkzeugkosten: Siehe Serviceseiten. D Digitaldruck 4c. Fläche: 70 x 7 Preis/Stk.:mm ab 400 Stück -,30 Datenhandling: einmalig 29,138 538 blau ab -,19 138 546 rot ab -,19 138 562 grün ab -,19 STÜCKAB STÜCK-PREIS 1.DRUCKFARBE DIGITAL4C 1 -,42 400 -,32 -,14 -,30 1.500 -,30 -,13 -,28 3.000 -,28 -,11 -,26 5.000 -,24 -,10 -,22 10.000 -,19 -,09-,20 Druckkosten weitere Farben: siehe Onlineshop 2 „ALBACETE“ALUMINIUM-SCHREIBER Dieser blauschreibende Kugelschreiber aus Aluminium begeistert nicht nur durch seine hochwertige Lackierung, sondern auch durch die silbernen Zierringe. W Werbedruck. Fläche: 40 x 10 mm Preis/Stk.: ab 200 Stück -,18 Werkzeugkosten: Siehe Serviceseiten. 170 431 silber ab -,49 170 440 schwarz ab -,49 170 458 blau ab -,49 170 466 rot ab -,49 170 474 grün ab -,49 STÜCKAB STÜCK-PREIS 1.DRUCKFARBE 1 -,67 200 -,60 -,18 500 -,57 -,17 1.500 -,53 -,15 3.000 -,49 -,12 Druckkosten weitere Farben: siehe Onlineshop 2 „ALBACETE“ALUMINIUM-SCHREIBER ab 0 49
ab 0 26
DRUCK4C 3 „JAVA“DRUCKKUGELSCHREIBER
Klippdruck-Kugelschreiber mit vollfarbenem Kunststoffgehäuse in kräftigen Farben. Silberfarbene KunststoffSpitze sowie Metall-Klipp und -ring. Blauschreibende Großraummine. W Werbedruck. Fläche: Gehäuse: 45 x 18 mm Preis/Stk.: ab 500 Stück -,14 Werkzeugkosten: Siehe Serviceseiten. 103 976 schwarz ab -,26 103 984 weiß ab -,26 104 016 gelb ab -,26 STÜCKAB STÜCK-PREIS 1.DRUCKFARBE 1 -,42 500 -,37 -,14 1.000 -,34 -,13 2.500 -,33 -,12 5.000 -,29 -,11 10.000 -,26 -,10 Druckkosten weitere Farben: siehe Onlineshop SCHREIBER „JAVA“ SCHREIBERDRUCKKUGEL-„JAVA“









































LEUCHTENDE WERBEANBRINGUNG LED-Switch 1 KUGELSCHREIBER „SWAY LUX“ INKL. LASERGRAVUR ab 0 59 Lieferung nur für den gewerblichen Bedarf. Alle Preise zzgl. MwSt.118 | SCHREIBER 2 „SMARTTOUCHDREHKUGELSCHREIBERCOLOR“ Kugelschreiber mit Touch-Pen, der an das Gehäuse farblich angepasst ist. S Siebdruck. Fläche: 38 x 12 mm Preis/Stk.: ab 200 Stück -,24 Werkzeugkosten: Siehe Serviceseiten. 151 040 schwarz ab -,35 151 058 blau ab -,35 151 066 rot ab -,35 151 074 weiß ab -,35 151 082 grün ab -,35 STÜCKAB STÜCK-PREIS 1.DRUCKFARBE 1 -,49 200 -,47 -,24 1.000 -,45 -,20 2.500 -,42 -,18 5.000 -,38 -,16 10.000 -,35 -,14 Druckkosten weitere Farben: siehe Onlineshop 2 „SMARTTOUCHDREHKUGELSCHREIBERCOLOR“ ab 0 35 1 KUGELSCHREIBER „SWAY LUX“ INKL. LASERGRAVUR Strahlender Auftritt für Ihr Firmenlogo. Der Touch-Kugelschreiber aus Kunststoff und Metall mit Drehmechanismus hat eine beleuchtete Logofläche, die Ihr gelasertes Firmenzeichen effektvoll leuchten lässt. Blauschreibend, mit Ein- und Ausschalter für das LED-Licht, inklusive Batterien.. L Lasergravur. Fläche: links vom Klipp 36 x 6 mm ab 100 Stk. Werzeugkosten: Siehe Serviceseiten 181 603 silber ab -,59 181 611 schwarz ab -,59 181 620 blau ab -,59 181 638 rot ab -,59 181 646 grün ab -,59 STÜCKAB INKL.GRAVURLASER100 1,39 250 1,29 500 1,09 1.500 -,99 3.000 -,79 6.000 -,59













































DRUCKDRUCK4C4C 200 184184„FUNKUGELSCHREIBERTOUCH“058blau066rot 129.-WERBETIPP* 2 „BRISTOL“TOUCH-SCHREIBER Klassischer Kugelschreiber und Touchpen zugleich - der Touch Schreiber „Bristol“ mit schwarzem Gummigriff ist ein idealer Begleiter im Berufs- und Privatleben. Blauschreibende Qualitätsmine. W Werbedruck. Fläche: 40 x 8 mm Preis/Stk.: ab 300 Stück -,17 Werkzeugkosten: Siehe Serviceseiten 133 698 schwarz ab -,19 133 663 blau ab -,19 133 671 rot ab -,19 133 680 silber ab -,19 STÜCKAB STÜCK-PREIS 1.DRUCKFARBE 1 -,32 300 -,28 -,17 1.000 -,26 -,16 2.000 -,24 -,14 5.000 -,21 -,12 10.000 -,19 -,10 Druckkosten weitere Farben: siehe Onlineshop 2 TOUCHSCHREIBER „BRISTOL“ ab 0 19 119SCHREIBER |* Komplettpreis inklusiv einfarbigem, einseitigen Werbeaufdruck in Standardschrift 3 „FUNDREHKUGELSCHREIBERTOUCH“ Drehkugelschreiber mit Touch-Pen. Spitze und Ringe sind aus verchromtem Kunststoff, Clip aus verchromtem Stahl. Blauschreibende Qualitätsmine. W Werbedruck. Fläche: 40 x 7 mm Preis/Stk.: ab 400 Stück -,19 Werkzeugkosten: Siehe Serviceseiten. D Digitaldruck 4c. Fläche: 40 x 7 mm Preis/Stk.: ab 400 Stück -,32 Datenhandling: einmalig 29,173 879 blau ab -,25 173 887 rot ab -,25 173 900 weiß ab -,25 STÜCKAB STÜCK-PREIS 1.DRUCKFARBE DIGITAL4C 1 -,40 400 -,35 -,19 -,32 1.000 -,33 -,18 -,30 2.500 -,30 -,15 -,28 5.000 -,28 -,13 -,24 10.000 -,25 -,11 -,22 Druckkosten weitere Farben: siehe Onlineshop 1 „INTERNATIONAL“HANDYHALTER/TOUCHDRUCKKUGELSCHREIBER Multifunktionaler Kugelschreiber mit Touch-Pen und Handyhalter. Blauschreibende Qualitätsmine. S Siebdruck. Fläche: 45 x 20 mm Preis/Stk.: ab 300 Stück -,16 W Werbedruck. Fläche: 40 x 7 mm Preis/Stk.: ab 300 Stück -,15 Werkzeugkosten: Siehe Serviceseiten. D Digitaldruck 4c. Fläche: 40 x 8 mm Preis/Stk.: ab 300 Stück -,35 Datenhandling: einmalig 29,175 288 schwarz ab -,19 175 296 weiß ab -,19 175 307 blau ab -,19 175 315 rot ab -,19 175 323 silber ab -,19 1 DRUCKKUGELSCHREIBER „INTERNATIONAL“ ab 0 19 STÜCKAB STÜCK-PREIS 1.DRUCKFARBE DIGITAL4C Druckkosten20.00010.0005.000-,25-,12-,282.0003001-,33–-,29-,16-,35-,27-,14-,32-,23-,10-,22-,19-,09-,19weitereFarben:sieheOnlineshop 3 „FUNDREHKUGELSCHREIBERTOUCH“ ab 0 25







































grau ab 1,85 2 SOFTTOUCH„STRAIGHTMETALLSCHREIBERGUM“ ab 1 85 STÜCKAB
1.DRUCKFARBE
Druckkosten2.0001.0003001005012,50–2,35-,70-,952,25-,65-,852,05-,50-,651,95-,40-,551,85-,30-,50weitereFarben:sieheOnlineshop
1,85 170
Druckkosten10.0005.0002.5001.0002501-,55–-,52-,18-,30-,50-,17-,27-,45-,15-,25-,42-,12-,22-,39-,10-,19weitereFarben:sieheOnlineshop 1 SOFT
Fläche: 40 x 6 mm Preis/Stk.: ab 250 Stück -,18 L Lasergravur. Fläche: 40 x 6 mm Preis/Stk.: ab 250 Stück -,30 Werkzeugkosten: Siehe Serviceseiten. 177 621 blau ab -,39 177 630 rot ab -,39 177 648 schwarz ab -,39 177 656 weiß ab -,39 177 664 hellgrün ab -,39 3 „FARO“,METALLSCHREIBERSOFTTOUCH ab 0 39 STÜCKAB
mit Metall-Clip nimmt man gerne in Hand. Die Soft-TouchOberfläche sorgt für eine besonders zarte Haptik. S Siebdruck. Fläche: 50 x 13 mm Preis/Stk.: ab 200 Stück -,25 L Lasergravur. Fläche: 40 x 5 mm Preis/Stk.: ab 200 Stück -,36 Werkzeugkosten: Siehe Serviceseiten. 190 382 schwarz ab -,42 190 399 grau ab -,42 190 403 blau ab -,42 190 411 orange ab -,42 190 420 rot ab -,42 STÜCKAB STÜCK-PREIS 1.DRUCKFARBE GRAVURLASER10.0001.0005002001-,65––-,60-,25-,36-,58-,22-,33-,56-,20-,302.500-,52-,18-,255.000-,47-,15-,22-,42-,12-,20DruckkostenweitereFarben:sieheOnlineshop
METALLSCHREIBER
2 UMA „STRAIGHT SOFTTOUCHGUM“
1.DRUCKFARBE
Lieferung nur für den gewerblichen Bedarf. Alle Preise zzgl. MwSt.120 | SCHREIBER 1 SOFT SCHREIBERTOUCH ab 0 42
Mit seiner samtig weichen SofttouchOberfläche liegt dieser Kugelschreiber besonders geschmeidig in den Händen. Blauschreibende Qualitätsmine. S Siebdruck. Fläche: auf Schaft, ca. 40 x 12 mm Preis/Stk.: ab 50 Stück -,70 L Lasergravur. Fläche: 50 x 5 mm Preis/Stk.: ab 50 Stück -,95 Werkzeugkosten: Siehe Serviceseiten. 170 739 schwarz ab 747 755 763 STÜCK-PREIS GRAVURLASER3 „FARO“,METALLSCHREIBERSOFTTOUCH Metall-Kugelschreiber mit besonders weicher Softtouch-Oberfläche. Schreibkomfort bieten auch die silbernen Metallringe in der Griffzone. Spitze, Clip und Drücker aus Metall, blauschreibend. W Werbedruck. STÜCK-PREIS GRAVURLASERTOUCH SCHREIBER Diesen blauschreibenden Kunststoffkugelschreiber
blau ab 1,85 170
rot ab 1,85 170




























































1 „ISABELA“METALLSCHREIBERALUSOFT Hochwertiger Kugelschreiber aus Aluminium und Softtouch-Oberfläche. Blauschreibende Qualitätsmine. W Werbedruck. Fläche: ca. 40 x 7 mm Preis/Stk.: ab 150 Stück -,40 Werkzeugkosten: Siehe Serviceseiten. 172 790 schwarz ab -,59 172 804 blau ab -,59 172 812 rot ab -,59 172 829 orange ab -,59 172 837 grau ab -,59 1 „ISABELA“METALL-SCHREIBERALUSOFT ab 0 59 STÜCKAB STÜCK-PREIS 1.DRUCKFARBE 1 -,95 150 -,89 -,40 500-,85 -,36 1.500-,79 -,30 5.000-,69 -,25 10.000 -,59 -,20 Druckkosten weitere Farben: siehe Onlineshop IM2SET 2 SCHREIBSETALUMINIUM Dieses zweiteilige Schreibset ist aus matt glänzendem Aluminium und enthält einen blauschreibenden Kugelschreiber sowie einen Druckbleistift. Lieferung in Präsentbox aus Karton W Werbedruck. Fläche: auf Box, 80 x 30 mm. Oder auf beide Schreiber, 40 x 7 mm Preis/Set: ab 60 Set -,50 Werkzeugkosten: Siehe Serviceseiten. 177 816 schwarz ab 1,49 177 824 blau ab 1,49 177 832 rot ab 1,49 177 849 weiß ab 1,49 SETAB PREISSET- 1.DRUCKFARBE 1 2,10 60 1,95 -,50 150 1,85 -,40 500 1,75 -,35 1.000 1,65 -,30 2.500 1,49 -,25 Druckkosten weitere Farben: siehe Onlineshop 2 SCHREIBSETALUMINIUMab 1 49 121SCHREIBER |


















































im Geschenketui im Geschenketui 25 PARKER 201201101KUGELSCHREIBERJOTTER858blau888schwarz896weiß 289.-WERBETIPP* 10 JOTTER EDELSTAHL inkl. 184StandardschriftLasergravur138 189.-WERBETIPP* Lieferung nur für den gewerblichen Bedarf. Alle Preise zzgl. MwSt.122 | SCHREIBER 3 PARKER SCHREIBSET ab 19 95 1 ORIGINAL PARKER JOTTER KUGELSCHREIBER Kunststoffunterteil. Kappe aus Edelstahl. Großraum-Metallmine. Geschenketui. W Werbedruck. Fläche: auf Schaft: 40 x 20 mm L Lasergravur. Fläche: Oberteil: 30 x 8 mm Preis/Stk.: ab 15 Stück 1,90 Werkzeugkosten: Siehe Serviceseiten. 012 656 blau ab 6,95 012 664 schwarz ab 6,95 034 194 weiß ab 6,95 STÜCKAB STÜCK-PREIS 1.DRUCKFARBE GRAVURLASER1 9,95 15 9,75 1,90 2,40 50 9,45 -,90 1,70 100 8,95 -,70 1,20 250 7,95 -,50 -,90 500 6,95 -,30-,50 Druckkosten weitere Farben: siehe Onlineshop 1 ORIGINAL PARKER JOTTER KUGELSCHREIBER ab 6 95 2 ORIGINAL PARKER „JOTTER EDELSTAHL“ Mattgebürstetes Edelstahlgehäuse. Original Parker Großraum-Metallmine. Geschenketui. L Lasergravur. Fläche: 30 x 8 mm Preis/Stk.: ab 10 Stück -,95 Werkzeugkosten: Siehe Serviceseiten. 012 736 ab 10,95 2 ORIGINAL PARKER „JOTTER EDELSTAHL“ ab 10 95 STÜCKAB STÜCK-PREIS GRAVURLASER1 14,95 10 13,95 2,50 10012,95 -,65 200 12,45 -,55 40011,95 -,45 800 10,95 -,35 3 PARKER „JOTTERSCHREIBSETEDELSTAHL“ 1 Set / 2 Teile Edles „Jotter Edelstahl“-Schreibset, bestehend aus einem Druckkugelschreiber mit blauschreibender, auswechselbarer Parker-Großraummine und einem Druckbleistift mit einer 0,5 mm-Mine. Die Lieferung erfolgt in einem Geschenketui. Maße: Etui ca. 17 x 6 x 2 cm L Lasergravur. Fläche: 30 x 8 mm Preis/Set: ab 5 Sets 4,95 Werkzeugkosten: Siehe Serviceseiten. 013 000 ab 19,95 SETAB PREISSET- GRAVURLASER1 29,95 5 28,95 4,95 30 26,95 2,50 100 24,95 1,95 20022,95 1,20 400 19,95 -,95 IM2SET
























MARKANT KugelschreiberundBleistift 123SCHREIBER |* Komplettpreis inklusiv einfarbigem, einseitigen Werbeaufdruck in Standardschrift 1 SCHREIBSET IM BLECHETUI „LACK“ ab 2 49 1 SCHREIBSET IM BLECHETUI „LACK“ Hochglanz in Set. Prächtig glänzend erscheint hier nicht nur das Blech-Etui in Lackoptik als Träger Ihrer Werbebotschaft sondern in gleicher Farbe auch der schwarzschreibende Kugelschreiber und der 5 mm Minenbleistift. Schönes Detail der Stifte sind die silbernen Ringe im Griffbereich. Maße: Etui 5,4 x 16 x 2 cm W Werbedruck. Fläche: auf Etui 50 x 15 mm. Preis/Set: ab 40 Sets -,60 S Siebdruck. Fläche: auf Schreiber 30 x 18 Preis/Set:mmab 40 Sets -,75 Werkzeugkosten: Siehe Serviceseiten. 121 572 schwarz ab 2,49 121 589 blau ab 2,49 121 597 rot ab 2,49 121 601 silber ab 2,49 STÜCKAB STÜCK-PREIS DRUCKETUI DRUCKSIEB1 3,50 40 3,25 -,60 -,75 150 3,15 -,55-,65 500 3,05 -,50-,55 1.000 2,49 -,40-,45 Druckkosten weitere Farben: siehe Onlineshop 3 „LINOX“METALL-KUGELSCHREIBER ab 1 19 STÜCKAB STÜCKPREIS 1.DRUCKFARBE 1 1,85 80 1,65 -,45 250 1,55 -,35 500 1,35 -,30 1.000 1,19 -,25 Druckkosten weitere Farben: siehe Onlineshop 3 „LINOX“METALL-KUGELSCHREIBER Schwerer Metallkugelschreiber mit markantem Griffprofil. Blauschreibende Großraummine. Mattglänzendes Gehäuse. S Siebdruck. Fläche: 50 x 12 mm Preis/Stk.: ab 80 Stück -,45 Werkzeugkosten: Siehe Serviceseiten. 271 990 ab 1,19 2 KUGELSCHREIBER mit Laserpointer und LED-Lampe Kugelschreiber mit 3-fach-Funktion.In eleganter Geschenkbox aus Holzimitat. Maße: Box 15,7 x 4,6 x 2 cm W Werbedruck. Fläche: auf Box: 80 x 25 mm Preis/Stk.: ab 40 Stück -,80 Ä Ätzung. Fläche: auf Schreiber: 30 x 7 mm Preis/Stk.: ab 40 Stück -,90 Werkzeugkosten: Siehe Serviceseiten. 284 129 ab 1,89 STÜCKAB STÜCK-PREIS 1.DRUCKFARBE ÄTZUNG 1 3,25 40 3,05 -,80 -,90 200 2,90 -,55-,65 500 2,55 -,45-,55 1.500 2,25 -,35-,45 5.000 1,99 -,25-,40 Druckkosten weitere Farben: siehe Onlineshop 50 KUGELSCHREIBER MIT LASER-POINTER, LED 285 931 219.-WERBETIPP*2 UNDMITKUGELSCHREIBERLASERPOINTERLED-LAMPE ab 1 89 IM2SET




























































Nachfüllbare 0,7 Bleistiftminemm 1 „LOOKALIKE“DRUCKBLEISTIFT ab0 26 1 DRUCKBLEISTIFT „LOOKALIKE“ Mit diesem Bleistift sind Sie auf dem Holzweg, er ist aus Kunststoff! Seine perfekte Holzoptik macht diesen Druckbleistift zu einem besonderen Hingucker und damit zu einem aufmerksamkeitsstarken Werbebotschafter. Mit Radiergummi als Drücker am Schaftende. Inkl. 0,7 mm Bleistiftmine. Nachfüllbar. W Werbedruck. Fläche: ca. 70 x 2 Preis/Stk.:mmab300 Stück -,14 Werkzeugkosten: Siehe Serviceseiten. 171 395 schwarz ab –,26 171 400 blau ab –,26 171 418 orange ab –,26 171 387 weiß ab –,26 STÜCKAB STÜCK-PREIS 1.DRUCKFARBE 1 -,39 300 -,35 -,14 1.000 -,32 -,12 3.000 -,29 -,10 5.000 -,28 -,09 10.000 -,26 -,08 Druckkosten weitere Farben: siehe Onlineshop Lieferung nur für den gewerblichen Bedarf. Alle Preise zzgl. MwSt.124 | SCHREIBER MADE GERMANYIN 2 KUGELSCHREIBER „BIO-MIX“ Blauschreibender Kugelschreiber aus Bio-Mix-Material. 70% des Stiftes sind Natur pur. Der Schaft besteht aus recyceltem Papier, der Klipp aus hellem Holz. Drucker und Spitze bestehen aus biologisch abbaubarem BIO-Material entspricht DIN EN 13432:2000-12. W Werbedruck. Fläche: auf Schaft, 40 x 12 mm, oder Klipp, 30 x 4 mm Preis/Stk.: ab 200 Stück -,16 Werkzeugkosten: Siehe Serviceseiten. 091 864 ab -,59 STÜCKAB STÜCK-PREIS 1.DRUCKFARBE 1 -,85 200 -,80 -,16 500 -,75 -,15 1.500 -,69 -,14 3.000-,65 -,12 5.000 -,59 -,11 Druckkosten weitere Farben: siehe Onlineshop 2 „BIO-MIX“KUGELSCHREIBER ab 0 59 3 TROIKA KUGELSCHREIBERCONSTRUCTION ab 10 95 3 TROIKA KUGELSCHREIBERCONSTRUCTION Multitasking Kugelschreiber & Touchpen mit Zentimeter- und Zoll-Lineal, 1:20 m und 1:50 m Skala, Wasserwaage, Schlitz- und Kreuzschraubendreher, Messing lackiert, mit schwarzer Mine. Maße: Ø 1 x 15 cm L Lasergravur. Fläche: 55 x 5 mm Preis/Stk.: ab 10 Stück 2,95 Werkzeugkosten: Siehe Serviceseiten. 142 543 silber ab 10,95 142 535 gelb ab 10,95 STÜCKAB STÜCK-PREIS GRAVURLASER1 16,49 10 15,25 2,95 50 13,95 1,95 100 12,45 1,50 250 11,95 1,20 500 10,95 -,90






































273 690 weiß ab
273 712 rot ab
SicherheitsverschlussKarabinerhakenKlarsichthülleSchnappverschluss STÜCKAB 4CINKL.DRUCK 100 2,65 300 2,35 500 2,05 1.000 1,85 5.000 1,45 10.000 1,19 125WERBEIDEEN |
2 SCHLÜSSELBAND (LANYARD) Praktisches Schlüsselband mit Schnapp- und Sicherheitsverschluss aus Kunststoff sowie abnehmbarem Schlüsselring mit Karabinerhaken. Ideal für Ihre Werbung. Am Karabinerhaken lassen sich z.B. Messeausweise, Hausschlüssel oder der Kugelschreiber befestigen. Lieferbar in 6 modischen Farben. SP Spezialdruck. Fläche: max. 4 Positionen, je 12 x 200 mm Preis/Stk. & Position.: ab 100 Stück -,47 Mehrfarbendruck auf Anfrage. Werkzeugkosten: Siehe Serviceseiten. -,59 -,59 -,59 -,59 -,59
273 704 schwarz ab
117 326 grün ab
Bitte gleich mitbestellen KLARSICHTHÜLLE FÜR LANYARDS Ob Firmenausweise, Namensschilder, Mitglieds- oder Eintrittskarten in dieser Klarsichthülle für Lanyards werden Ausweise und Schilder zum gut sichtbaren Begleiter auf Veranstaltungen, Messen oder im Arbeitsalltag. Maße: 10 x 8 -,29 sichtbaren Veranstaltun-
273 681 blau ab
–
117 334 gelb ab -,59
cm 170 587
1 POLYESTER-LANYARD inkl. 4C-Druck, 2-seitig Unendliche Gestaltungsmöglichkeiten machen dieses klassischen Lanyard mit abnehmbarem verfahrenauchlassenDieschlussKarabinerhakenKunststoffverschluss,undSicherheitsver-zumperfektenWerbemittel.Besonderheit:DieseLanyardssichsowohlaufderVorder-alsderRückseiteimTransferdruck-individualisieren. Maße: 57 x 2 Mindestbestellmengecm 100 Stück. Keine weiteren Werkzeugkosten. Lieferzeit ca. 3 Wochen. 152 796 ab 1,19 1 INKL.LANYARDPOLYESTER-4C-DRUCK ab 1 19 STÜCKAB STÜCK-PREIS 1.DRUCKFARBE 1 1,25 100 -,99 -,47 500 -,89 -,37 1.000 -,69 -,35 5.000 -,59 -,32 Druckkosten weitere Farben: siehe Onlineshop 2 LANYARDSCHLÜSSELBAND ab 0 59 Bitte gleich mitbestellen KLARSICHTHÜLLE FÜR LANYARDS Ob Firmenausweise, Namensschilder, Mitglieds- oder Eintrittskarten – in dieser Klarsichthülle für Lanyards werden Ausweise und Schilder zum gut
Begleiter auf
gen, Messen oder im Arbeitsalltag. Maße: 10 x 8 cm 170 587 -,29








































































Kapselheber Lieferung nur für den gewerblichen Bedarf. Alle Preise zzgl. MwSt.126 | WERBEIDEEN 2 KAPSELHEBER FEUERZEUG Auf dieses Feuerzeug haben wir lange gewartet. Denn dank integriertem Kapselheber öffnet es zugleich jede Bierflasche. W Werbedruck. Fläche: 50 x 10 mm Preis/Stk.: ab 400 Stück -,16 Werkzeugkosten: Siehe Serviceseiten. D Digitaldruck 4c. Fläche: 50 x 11 mm Preis/Stk.: ab 400 Stück -,40 Datenhandling: einmalig 29,134 238 blau ab -,29 134 246 rot ab -,29 134 254 weiß ab -,29 134 262 gelb ab -,29 3 FEUERZEUG „COLOURED KNOB“ Schlichtes schwarzes Feuerzeug mit einem auffälligen Druckknopf in unterschiedlichen Farben. Ob in rot, blau, gelb oder grün – alle Druckknöpfe sind mit einer Kindersicherung versehen. Nachfüllbar, kindergesichert. Maße: 8 x 2,3 x 0,8 cm W Werbedruck. Fläche: 50 x 12 mm Preis/Stk.: ab 400 Stück -,18 Werkzeugkosten: Siehe Serviceseiten. 123 654 schwarz/rot ab -,19 123 662 schwarz/blau ab -,19 123 679 schwarz/gelb ab -,19 123 687 schwarz/grün ab -,19 2 KAPSELHEBER FEUERZEUG ab 0 29 3 „COLOUREDFEUERZEUG KNOB“ ab 0 19 1 PIEZO „SILVER“FEUERZEUG ab 0 28 1 PIEZO-FEUERZEUG „SILVER“ Feuerzeug mit elektronischer Piezo-Zündung in trendigem Silver-Look. Flammhöhe regulierbar. Nachfüllbar. Gehäuse aus silberfarbenem Kunststoff, Drücker und Bodenteil farbig. Verchromte Metallschutzkappe. Große Werbefläche. Maße: 8 x 2,5 x 1 cm W Werbedruck. Fläche: 45 x 12 Preis/Stk.:mmab 300 Stück -,15 Werkzeugkosten: Siehe Serviceseiten. 091 889 blau ab -,28 091 897 rot ab -,28 091 910 schwarz ab -,28 STÜCKAB STÜCK-PREIS 1.DRUCKFARBE 1 -,42 300 -,37 -,15 1.000 -,35 -,14 2.500 -,32 -,13 5.000 -,30 -,12 10.000 -,28 -,11 Druckkosten weitere Farben: siehe Onlineshop STÜCKAB STÜCK-PREIS 1.DRUCKFARBE 1 -,33 400 -,26 -,18 1.000 -,24 -,15 5.000 -,23 -,13 10.000 -,21 -,12 20.000 -,19 -,11 Druckkosten weitere Farben: siehe Onlineshop STÜCKAB STÜCK-PREIS 1.DRUCKFARBE DIGITAL4C 1 400-,42-,47 -,16 -,40 1.000-,38 -,15 -,35 2.500-,36 -,14 -,30 5.000-,33 -,13 -,25 10.000-,29 -,12 -,20 Druckkosten weitere Farben: siehe Onlineshop DRUCK4C



































127WERBEIDEEN | 3 PIEZO FEUERZEUG „ATOMIC F2“ Ob in Silber oder Blau, Rot, Weiß oder mattem Schwarz – das Piezo Feuerzeug ist vom Zündmechanismus bis hin zum Gehäuse komplett einfarbig, so dass Ihre Werbeanbringung besonders gut zur Geltung kommt. Maße: 2,5 x 8 x 1 cm W Werbedruck. Fläche: 45 x 12 mm Preis/Stk.: ab 400 Stück -,16 Werkzeugkosten: siehe Serviceseiten. 151 371 silber ab -,23 151 380 blau ab -,23 151 398 rot ab -,23 151 402 weiß ab -,23 151 419 schwarz matt ab -,23 1 PIEZO-FEUERZEUG „GO“ Mit diesem klassischen Piezo-Feuerzeug verbreitet sich Ihre Werbebotschaft wie ein Lauffeuer. Bei diesem Preise-Hit muss man einfach Feuer und Flamme sein! Maße: 2,5 x 8 cm W Werbedruck. Fläche: 50 x 14 mm Preis/Stk.: ab 600 Stück -,14 Werkzeugkosten: siehe Serviceseiten. D Digitaldruck 4c. Fläche: 55 x 15 mm Preis/Stk.: ab 600 Stück -,40 Datenhandling: einmalig 29,153 086 weiß ab -,15 153 094 blau ab -,15 153 109 rot ab -,15 153 117 gelb ab -,15 153 125 schwarz ab -,15 3 „ATOMICPIEZO-FEUERZEUGF2“ ab 0 23 STÜCKAB STÜCK-PREIS 1.DRUCKFARBE DIGITAL4C 1 600--,29,25 -,14 -,40 1.500-,24 -,13 -,35 5.000-,21 -,12 -,31 10.000-,18 -,11 -,29 20.000-,15 -,10 -,25 Druckkosten weitere Farben: siehe Onlineshop STÜCKAB STÜCK-PREIS 1.DRUCKFARBE 1 -,39 400 ,35 -,17 1.000 -,32 -,16 2.500 ,29 -,13 5.000 -,25 -,12 10.000 ,23 -,11 Druckkosten weitere Farben: siehe Onlineshop 1 PIEZO FEUERZEUG „GO“ ab 0 15 2 FEUERZEUG „SOFT TOUCH“ Dank softer Gummioberfläche liegt dieses nachfüllbare Feuerzeug besonders angenehm in der Hand –wahlweise mit einem Zündmechanismus in grün, blau, pink oder rot. W Werbedruck. Fläche: 50 x 12 Preis/Stk.:mmab 300 Stück -,19 Werkzeugkosten: Siehe Serviceseiten. 186 336 grün ab -,24 186 344 blau ab -,24 186 352 pink ab -,24 186 369 rot ab -,24 194 682 schwarz ab -,24 STÜCKAB STÜCK-PREIS 1.DRUCKFARBE 1 -,42 300 -,38 -,19 1.000 -,35 -,18 2.500 -,33 -,17 5.000 -,29 -,15 10.000 -,24 -,12 Druckkosten weitere Farben: siehe Onlineshop 2 FEUERZEUG„SOFTTOUCH“ ab 0 24 DRUCK4C












































weißeLeuchteLEDden gewerblichen Bedarf. Alle Preise zzgl. MwSt. 3 „LIGHT & FIRE“ PIEZO-FEUERZEUGLEDPiezo-Feuerzeug mit weißer LED-Leuchte (Batterie enthalten). Feuerzeug nachfüllbar, Flammhöhe verstellbar. Kindergesichert. Maße: ca. 8 x 2,5 x 1 cm W Werbedruck. Fläche: ca. 40 x 7 Preis/Stk.:mmab250 Stück -,17 Werkzeugkosten: Siehe Serviceseiten. 287 437 blau ab -,36 287 445 silber ab -,36 287 453 schwarz ab -,36 287 461 rot ab -,36 1 PIEZO-FEUERZEUG „PROMO” Der Klassiker unter den Feuerzeugen. Hochwertige Piezo-Zündung. Nachfüllbar. Kindergesichert. Kunststoffgehäuse. FlammenhöheDoppelkammer-Gastank.regulierbar. Maße: 8 x 2,5 x 1 cm W Werbedruck. Fläche: 50 x 13 mm Preis/Stk.: ab 400 Stück -,16 Werkzeugkosten: Siehe Serviceseiten. 083 467 weiß ab -,24 083 475 schwarz ab -,24 083 491 blau ab -,24 083 506 rot ab -,24 083 514 gelb ab -,24 STÜCK-PREIS -,39 400 -,33 -,17 2.500 -,30 -,15 -,26 -,14 10.000 -,24 -,12 Druckkosten weitere Farben: siehe Onlineshop STÜCKAB STÜCK-PREIS 1.DRUCKFARBE 1 -,52 250 -,46 -,17 1.000 -,44 -,15 2.000 -,42 -,14 5.000 -,39 -,13 10.000 -,36 -,12 Druckkosten weitere Farben: siehe Onlineshop
Lieferung nur für
5.000
1 „PROMO“PIEZO-FEUERZEUG ab 0 24 3 „ LIGHT & FIRE“ PIEZO-FEUERZEUGLEDab 0 36 2 „ATOMICFEUERZEUGSWING“ Das matte und formschöne Kunststofffeuerzeug hat einen geschwungenen Zündmechanismus und lässt sich nachfüllen. W Werbedruck. Fläche: 50 x 15 mm Preis/Stk.: ab 300 Stück -,17 Werkzeugkosten: Siehe Serviceseiten. D Digitaldruck 4c. Fläche: 50 x 15 Preis/Stk.:mmab 300 Stück -,35 Datenhandling: einmalig 29,186 377 rot ab -,28 186 385 blau ab -,28 186 393 schwarz ab -,28 186 408 weiß ab -,28 2 SWING“„ATOMICFEUERZEUG ab 0 28 STÜCKAB STÜCK-PREIS 1.DRUCKFARBE DIGITAL4C Druckkosten10.0005.0002.5001.0003001-,42––-,38-,17-,35-,36-,16-,32-,34-,15-,30-,32-,14-,28-,28-,12-,24weitereFarben:sieheOnlineshop DRUCK4C
128 | WERBEIDEEN
STÜCKAB
1.DRUCKFARBE 1














































































3 „FLAT“PIEZO-FEUERZEUG ab 0 24 300 162&sortiertPIEZO-FEUERZEUGEblau,rotschwarz257 175.-WERBETIPP* EINWIRDFEUERZEUGÜBERALLGEBRAUCHT 129WERBEIDEEN | 2 NACHFÜLLBARES PIEZOFEUERZEUG, VOLLFARBEN Mit Doppelkammergastank, verstellbarer Flammenhöhe und Metallschutzkappe. Angenehm gerundetes Kunststoffgehäuse. TÜV-/GS-geprüft. Maße: 2,5 x 8 x 1 cm W Werbedruck. Fläche: 50 x 13 mm Preis/Stk.: ab 400 Stück -,16 Werkzeugkosten: Siehe Serviceseiten. D Digitaldruck 4c. Fläche: 55 x 15 mm Preis/Stk.: ab 400 Stück -,40 Datenhandling: einmalig 29,201 214 blau/schwz. ab -,24 201 222 schwarz ab -,24 201 239 rot/schwarz ab -,24 201 255 weiß ab -,24 1 TURBO-GLUT-FEUERZEUG Das praktische „Outdoor“-Feuerzeug! Durch die Glutzündung kann auch bei Wind und Wetter bequem gezündet werden. Piezo-Zündung, Gastank nachfüllbar, Flamme regulierbar. Oberteil aus schwarz lackiertem Metall, Drücker und Gehäuse Kunststoff, farbig lackiert. Maße: ca. 2,5 x 8 x 1 cm W Werbedruck. Fläche: 50 x 15 mm Preis/Stk.: ab 300 Stück -,16 Werkzeugkosten: Siehe Serviceseiten. 105 394 weiß ab -,29 105 409 schwarz ab -,29 105 417 silber ab -,29 2 PIEZO-FEUERZEUGNACHFÜLLBARES ab 0 24 1 TURBO-GLUT FEUERZEUG ab 0 29STÜCKAB STÜCK-PREIS 1.DRUCKFARBE 1 -,48 300 -,42 -,17 1.000 -,39 -,15 2.500 -,36 -,14 5.000 -,32 -,12 10.000 -,29 -,11 Druckkosten weitere Farben: siehe Onlineshop STÜCKAB STÜCK-PREIS 1.DRUCKFARBE DIGITAL4C 10.0005.0003.0001.0004001-,39–-,34-,16-,40-,33-,14-,35-,29-,13-,30-,27-,12-,25-,24-,11-,20DruckkostenweitereFarben:sieheOnlineshop 3 PIEZO-FEUERZEUG „FLAT“ Feuerzeug in drei verschiedenen Metallic-Farben. Nachfüllbar. Flammenhöhe regulierbar. Mit Piezo-Zündung. Maße: ca. 8 x 2,5 cm W Werbedruck. Fläche: 50 x 15 mm Preis/Stk.: ab 400 Stück -,15 Werkzeugkosten: Siehe Serviceseiten. 051 959 blau ab -,24 051 991 silber ab -,24 051 975 anthrazit ab -,24 STÜCKAB STÜCK-PREIS 1.DRUCKFARBE 1 -,42 400 -,39 -,15 1.000 -,35 -,14 3.000 -,29 -,13 5.000 -,27 -,12 10.000 -,24 -,11 Druckkosten weitere Farben: siehe Onlineshop 400 282282„FLAT“PIEZO-FEUERZEUGE352blau369silber 239.-WERBETIPP* * Komplettpreis inklusiv einfarbigem, einseitigen Werbeaufdruck in Standardschrift DRUCK4C


















































Lieferung nur für den gewerblichen Bedarf. Alle Preise zzgl. MwSt.130 | WERBEIDEEN
175
PIEZO-FEUERZEUG
hochwertiger und komfortabler Soft-Piezo-Zündung. Hochaktuelle gefrostete Farben und silberne Kappe. Große Werbefl äche für optimalen Werbedruck. Kunststoffgehäuse mit Doppelkammergastank. Verstellbare Flammenhöhe. Flache, handsympathische Form. Maße: ca. 8 x 2,5 x 1 cm W Werbedruck. Fläche: 14 x 55 mm Preis/Stk.: ab 400 Stück -,15 Werkzeugkosten: Siehe Serviceseiten. 010 069 frosty blau ab -,21 010 237 frosty rot ab -,21 010 358 frosty gelb ab -,21 172 513 frosty weiß ab -,21 172 521 frosty hellgrün ab -,21 STÜCKAB STÜCK-PREIS 1.DRUCKFARBE 1 -,39 400 -,34 -,15 2.500 -,29 -,14 5.000 -,27 -,13 10.000 -,24 -,13 20.000 -,21 -,12 Druckkosten weitere Farben: siehe Onlineshop STÜCKAB STÜCK-PREIS 1.DRUCKFARBE 1 -,22 500 -,17 -,14 2.500 -,15 -,13 5.000 -,14 -,12 10.000 -,12 -,10 20.000 -,10 -,09 Druckkosten weitere Farben: siehe Onlineshop 1 PIEZO „FROSTY“FEUERZEUG ab 0 21 2 EINWEG- GASFEUERZEUG „GO“ ab 0 10 400 015FEUERZEUGEPIEZO-089blau 219.-WERBETIPP* 600 205gemischttransparentZEUGEGASFEUER-EINWEG-„GO“586 209.-WERBETIPP*1.000 065gemischttransparentZEUGEGASFEUER-EINWEG-„GO“205 329.-WERBETIPP*
1 „FROSTY“ Elektronisches Feuerzeug der Spitzenklasse mit
2 EINWEG-GASFEUERZEUG „GO“ Kunststoffgehäuse mit Doppelkammergastank. Flache, handsympathische Form mit abgerundeten Ecken und Kanten. Schutzkappe und Reibradzündung aus Metall. Flammenhöhe verstellbar. Maße: ca. 8 x 2,2 x 1 cm W Werbedruck. Fläche: 50 x 13 mm Preis/Stk.: ab 500 Stück -,14 Werkzeugkosten: Siehe Serviceseiten. 020 blau363transparent ab -,10 020 371 rot transparent ab -,10 020 grün380transparent ab -,10 013 gemischt421 transparent ab -,10 013 gemischt333 vollfarben ab -,10 020 486 weiß ab -,10 034 629 blau ab -,10 034 637 rot ab -,10 034 653 gelb ab -,10 921 schwarz ab -,10























































3 „FLEXI“STABFEUERZEUG ab 1 59DRUCK4C 131WERBEIDEEN |* Komplettpreis inklusiv einfarbigem, einseitigen Werbeaufdruck in Standardschrift 3 STABFEUERZEUG „FLEXI“ Nachfüllbares Piezo-Stabfeuerzeug mit langem flexiblen „Hals“; ideal für den Ofen, als Kerzenanzünder oder schwer zugängliche Teile. Flammenhöhe stufenlos regelbar, Lockfunktion. Sichtfenster für den Gas-Füllstand. Maße: 24 x 4,5 x 1,5 cm W Werbedruck. Fläche: 50 x 10 mm Preis/Stk.: ab 50 Stück -,70 Werkzeugkosten: Siehe Serviceseiten. 094 806 silber ab 1,59 STÜCKAB STÜCK-PREIS 1.DRUCKFARBE 1 2,49 50 2,29 -,70 250 2,19 -,60 1.000 1,89 -,45 2.000 1,59 -,35 Druckkosten weitere Farben: siehe Onlineshop 2 „BERGAMO“MINI-STABFEUERZEUG Kleines Stabfeuerzeug, auf dessen Kunststoffhülle Ihr Firmenlogo bestens zur Geltung kommt. Nachfüllbar. Maße: 3 x 11 x 1,4 cm W Werbedruck. Fläche: 30 x 13 mm Preis/Stk.: ab 200 Stück -,19 Werkzeugkosten: Siehe Serviceseiten. D Digitaldruck 4c. Fläche: 30 x 10 mm Preis/Stk.: ab 200 Stück -,42 Datenhandling: einmalig 29,172 476 weiß ab -,39 172 484 schwarz ab -,39 STÜCKAB STÜCK-PREIS 1.DRUCKFARBE DIGITAL4C 1 -,69 200 -,58 -,19 -,42 500 -,52 -,17 -,38 1.000 -,47 -,16 ,-35 3.000 -,43 -,14 -,30 5.000 -,39 -,12 ,-25 Druckkosten weitere Farben: siehe Onlineshop 2 MINI-STABFEUERZEUG „BERGAMO“ ab 0 39DRUCK4C 1 PIEZO „CANDLE LITE“ Diese Werbeidee zündet! Das nachfüllbare PiezoKerzenfeuerzeug hat einen Kunststoffkörper für Ihre Werbebotschaft. Feste Flammenhöhe. W Werbedruck. Fläche: 32 x 15 mm Preis/Stk.: ab 200 Stück -,24 Werkzeugkosten: Siehe Serviceseiten. D Digitaldruck 4c. Fläche: 40 x 20 mm Preis/Stk.: ab 200 Stück -,55 Datenhandling: einmalig 29,166 201 schwarz ab -,49 166 210 silber ab -,49 166 228 blau ab -,49 STÜCKAB STÜCK-PREIS 1.DRUCKFARBE DIGITAL4C 1 -,73 200 -,69 -,24 -,55 1.000 -,67 -,20 -,50 2.500 -,60 -,19 -,40 5.000 -,49 -,16 -,30 Druckkosten weitere Farben: siehe Onlineshop 1 PIEZO „CANDLE LITE“ ab 0 49



































X-Bogen dank 4 Kontaktpunkten 3 „JETSTURMFEUERZEUGFLAME“SOFTTOUCH Dieses klassische Jet-Flame Sturmfeuerzeug ist mit einer soften AntirutschBeschichtung überzogen, die für eine samtig-weiche Haptik sorgt. Nachfüllbar. Maße: 4 x 6,5 x 2 cm W Werbedruck. Fläche: 30 x 20 mm Preis/Stk.: ab 100 Stück -,49 Werkzeugkosten: Siehe Serviceseiten. D Digitaldruck 4c. Fläche: 30 x 20 Preis/Stk.:mmab 100 Stück 1,05 Datenhandling: einmalig 29,171 539 weiß ab -,85 171 547 schwarz ab -,85 171 555 blau ab -,85 172 425 rot ab -,85 STÜCKAB STÜCK-PREIS 1.DRUCKFARBE DIGITAL4C 10011,351,25 -,49 1,05 5001,15 -,45 -,95 1.000 1,09 -,35-,85 2.500-,95 -,25 -,75 5.000 -,85 -,20-,60 Druckkosten weitere Farben: siehe Onlineshop Lieferung nur für den gewerblichen Bedarf. Alle Preise zzgl. MwSt.132 | WERBEIDEEN 1 „JET“STURM-FEUERZEUG ab 0 79 1 STURMFEUERZEUG „JET“ Das Sturmfeuerzeug in knalliger Kunststoffhülle ist ein echter Handschmeichler, der auch bei starkem Wind zuverlässig zündet! Nachfüllbar. Maße: 4 x 7 x 2 cm W Werbedruck. Fläche: 30 x 18 mm Preis/Stk.: ab 100 Stück -,32 Werkzeugkosten: Siehe Serviceseiten. 172 433 weiß ab -,79 172 441 rot ab -,79 172 450 blau ab -,79 172 468 schwarz ab -,79 STÜCKAB STÜCK-PREIS 1.DRUCKFARBE 10011,391,29 -,32 250 1,19 -,27 500 1,09 -,24 1.000 -,99 -,22 2.500 -,89 -,19 5.000-,79 -,17 Druckkosten weitere Farben: siehe Onlineshop 2 FORMULALICHTBOGENFEUERZEUGARC Feuerzeug im klassischen Zipperdesign aus Edelstahl mit hochmodernem Innenleben. Denn statt Gas oder Benzin entflammt ein elektrischer Lichtbogen in Form eines Kreuzes Kamin, Kerzen & Co. USB-Kabel inklusive. Maße: 3,4 x 7,1 x 1,2 cm W Werbedruck. Fläche: 25 x 20 mm Preis/Stk.: ab 12 Stück 2,80 L Lasergravur. Fläche: 25 x 30 mm Preis/Stk.: ab 12 Stück 2,80 Werkzeugkosten: Siehe Serviceseiten. 194 393 silber ab 6,65 194 408 schwarz ab 6,65 194 416 blau ab 6,65 STÜCKAB STÜCK-PREIS 1.DRUCKFARBE GRAVURLASER1219,959,45 2,802,80 30 8,95 2,402,40 100 8,45 1,951,95 300 7,25 1,501,50 500 6,65 -,95-,95 Druckkosten weitere Farben: siehe Onlineshop 2 LICHTBOGEN FEUERZEUG FORMULA ARC ab 6 65 DRUCK4C 3 „JETSTURMFEUERZEUGFLAME“ ab 0 85





















































































133WERBEIDEEN | Klein Groß 2 STREICHHOLZSCHACHTELN inklusive Werbedruck Ihr Werbedruck ist bereits im Preis inbegriffen. Innendruck ist möglich für -,03 Aufpreis pro Farbe und Stück. Werkzeugkosten: 58,- pro Druckfarbe. Lieferzeit: ca. 4 Wochen. Die Druckkosten beinhalten den Druck auf Ober-, Unter- und eine Schmalseite. Grundfarbe Weiß. Bei abweichender Farbe gilt diese als erste Druckfarbe. Streichholzschachtel groß Maße: 56 x 36 x 8 mm 183 797 ab -,11 Streichholzschachtel klein Maße: 56 x 24 x 8 mm 183 789 ab -,10 Streichholzschachtel Dreieck Maße: 55 x 25 x 25 mm 177 701 ab -,14 Dreieck 2 SCHACHTELSTREICHHOLZab 0 10 Streichholzschachtel groß: 56 x 36 x 8 mm STÜCKAB PREIS1C PREIS2C PREIS3C PREIS4C 2.500 -,23 -,28 -,34-,39 10.000-,13-,15-,16-,175.000-,14-,16-,18-,2020.000-,11-,12-,14-,15 Streichholzschachtel klein: 56 x 24 x 8 mm STÜCKAB PREIS1C PREIS2C PREIS3C PREIS4C 2.500-,21 -,24 -,28 -,32 10.000-,12-,13-,14-,155.000-,13-,15-,16-,1720.000-,10-,11-,12-,13 Streichholzschachtel Dreieck: 55 x 25 x 25 mm STÜCKAB PREIS1C PREIS2C PREIS3C PREIS4C 1.000500-,79-,88-,971,05 -,44 -,48-,51-,54 2.500-,31 -,36 -,40 -,44 5.000-,19 -,22-,24-,26 10.000-,18-,19-,20-,2120.000-,14-,15-,16-,17 GOLDENE IDEEN FÜR IHRE KUNDEN 1 „GOLDBARREN“PIEZO-FEUERZEUG Piezo-Feuerzeug in Form eines Goldbarrens mit einer auffälligen Prägung. Feuerzeug nachfüllbar, Flammhöhe verstellbar. Lieferung erfolgt in einer eleganten, schwarzen Geschenkverpackung mit Sichtfenster. Maße: ca. 6,5 x 2,5 x 1 cm L Lasergravur. Fläche: 38 x 14 mm Preis/Stk.: ab 50 Stück -,95 Werkzeugkosten: Siehe Serviceseiten. 084 335 ab 2,15 1 „GOLDBARREN“PIEZO-FEUERZEUG ab 2 15 STÜCKAB STÜCK-PREIS GRAVURLASER1 3,15 50 3,05 -,95 200 2,95 -,85 500 2,75 -,75 1.000 2,45 -,65 2.500 2,15 -,50







































































































Lieferung nur für den gewerblichen Bedarf. Alle Preise zzgl. MwSt.134 | WERBEIDEEN 72 154„CARINA“KAFFEEBECHER169weiss 345.-1WERBETIPP*KAFFEEBECHER „CARINA“ Keramik. Spülmaschinengeeignet. Maße: ca. Ø 8 x 9,5 cm Füllmenge: 250 ml W Werbedruck. Fläche: 191 x 75 mm, spülmaschinengeeignet Preis/Stk.: ab 72 Stück für die erste Farbe 2,40 für jede weitere Farbe -,49 Einmalige Werkzeugkosten pro Farbe 55,Ohne Werbedruck im Einzelkarton 052 791 blau 2,95 052 783 gelb 2,95 052 775 rot/weiß 2,95 Für EinzeltasseWerbedruck 187 546 blau ab 1,95 187 520 gelb ab 1,95 187 503 rot/weiß ab 1,95 2 KAFFEEBECHER „CARINA“ Keramik. Spülmaschinengeeignet. Maße: ca. Ø 8 x 9,5 cm W Werbedruck. Fläche: 155 x 60 mm, spülmaschinengeeignet Preis/Stk.: ab 72 Stück für die erste Farbe 2,40 für jede weitere Farbe -,49 Einmalige Werkzeugkosten pro Farbe 55,Ohne Werbedruck im Einzelkarton 106 313 weiß 2,30 284 475 schwarz 2,85 175 930 grau/weiß 2,85 Für EinzeltasseWerbedruck 272 040 weiß ab -,99 284 467 schwarz ab 1,99 175 948 grau/weiß ab 1,99 1 „CARINA“,KAFFEEBECHERBUNT ab 1 95 2 „CARINA“,KAFFEEBECHERWEISS ab 0 99 2 KAFFEEBECHER „CARINA“, SCHWARZ ODER GRAU ab1 99 STÜCKAB STÜCK-PREIS 1.DRUCKFARBE WEITEREFARBE 722,60 2,40 -,49 1442,35 1,60 -,47 2882,25 1,50 -,45 5762,10 1,30 -,42 1.1521,95 1,20 -,39 STÜCKAB WEISSPREIS FARB.PREIS 1.DRUCKFARBE WEITEREFARBE 721,693,15 2,40 -,49 144 1,65 3,05 1,60 -,47 288 1,59 2,95 1,50 -,45 5761,492,79 1,30 -,42 1.152 1,39 2,49 1,20 -,39 2.304 -,99 1,99 1,10 -,35 72 098098098„CARINA“KAFFEEBECHER333rot341gelb350blau 399.-WERBETIPP*
















































im Einzelkarton 098 122 2,65 für EinzeltasseWerbedruck, 098 114 ab 1,79 2 PORZELLANTASSE „LISA“ ab 1 79 STÜCKAB STÜCK-PREIS 1.DRUCKFARBE WEITEREFARBE 72 2,49 2,40 -,49 144 2,39 1,60 -,46 288 2,19 1,50 -,45 5762,09 1,30 -,42 1.152 1,99 1,20 -,39 2.3041,79 1,10 -,35 ZUHAUSE ODER UNTERWEGS AUS DIESEN GEFÄSSEN MACHT ES SPASS ZU TRINKEN 72 043gefrostetKAFFEEBECHER357weiss 349.-WERBETIPP* 3 TRINKGLAS PICK UP Trinkbecher aus Glas mit abnehmbarem farbigen Deckel aus Silikon mit integrierter Trinköffnung, Silikon-Manschette für optimale Griffigkeit. Füllmenge: ca. 350 ml Material: Glas / Silikon Maße: Ø 8,5 x 11 cm L Lasergravur. Fläche: 45 x 15 mm auf Glas Preis/Stk.: ab 40 Stück 2,10 Werkzeugkosten: Siehe Serviceseiten. 205 990 schwarz ab 1,99 206 031 orange ab 1,99 206 007 blau ab 1,99 206 015 rot ab 1,99 206 023 grün ab 1,99 STÜCKAB STÜCK-PREIS GRAVURLASER1 3,55 40 3,05 2,10 80 2,85 1,95 150 2,65 1,35 300 2,50 -,95 600 2,25 -,60 1.200 1,99 -,30 3 TRINKGLAS PICK UP ab 1 99
ohne
* Komplettpreis inklusiv einfarbigem, einseitigen Werbeaufdruck in Standardschrift 135WERBEIDEEN | 1 WEISS„SNOWKAFFEEBECHERQUEEN“GEFROSTET Breiter, stabiler Becher aus weißem gefrostetem Glas. Maße: ca. Ø 8 x 9,5 cm Füllmenge: ca. 250 ml W Werbedruck. Fläche: 62 x 75 mm, spülmaschinengeeignet Preis/Stk.: ab 72 Stück für die erste Druckfarbe 2,40 für jede weitere Farbe -,49 Einmalige Werkzeugkosten pro Farbe: 55,Lieferzeit ca. 3-4 Wochen. ohne Werbedruck, im 050Einzelkarton062 2,15 Für 050EinzeltasseWerbedruck,079 ab 1,29 1 „SNOWKAFFEEBECHERQUEEN“ ab 1 29 STÜCKAB STÜCK-PREIS 1.DRUCKFARBE WEITEREFARBE 721,79 2,40 -,49 144 1,69 1,60 -,46 288 1,59 1,50-,45 5761,49 1,30 -,42 1.152 1,39 1,20 -,39 2.3041,29 1,10 -,35
2 PORZELLAN-TASSE „LISA“ Formschöner Porzellanbecher in konischer Form. Breiter Henkel auch gut für zusätzliche Werbung geeignet (z.B. www-Adresse), Innendruck möglich (beides auf Anfrage). Spülmaschinengeeignet. Maße: ca. Ø 7,8 x 10 cm Füllmenge: ca. 250 ml W Werbedruck. Fläche: links vom Henkel, 42 x 55 mm, spülmaschinengeeignet W Werbedruck. Fläche: rundum, 158 x 55 Preis/Stk.:mmab 72 Stück für die erste Farbe 2,40 jede weitere Druckfarbe -,49 Eimalige Werkzeugkosten: 55,-/Farbe Lieferzeit ca. 3-4 Wochen. Werbedruck,


































Lieferung nur für den gewerblichen Bedarf. Alle Preise zzgl. MwSt.136 | GANZWERBEIDEENNACH IHREM GESCHMACK CLEAN ODER MIT IHREM BEDRUCKTLOGO 1 KERAMIKBECHER „ELISE“ ab 1 59 1 KERAMIKBECHER „ELISE“ Keramikbecher in ausgefallener, konischer Form. Durch seinen breiten Henkel hält man diese Tasse jederzeit gut in der Hand. Maße: ca. Ø 7,8 x 10 cm. Füllmenge: 250 ml W Werbedruck. Fläche: 158 x 55 mm, spülmaschinengeeignet Preis/Stk.: ab 72 Stück für die erste Farbe 2,40 für jede weitere Farbe -,49 Werkzeugkosten pro Farbe: 55,Ohne Werbedruck, im Einzelkarton 283 626 weiß 2,50 Für Werbedruck, Einzeltasse 283 618 weiß ab 1,59 STÜCKAB WEISSETASSE 1.DRUCKFARBE WEITEREFARBE 721,89 2,40 -,49 1441,85 1,60 -,46 2881,79 1,50 -,45 5761,69 1,30 -,42 1.1521,59 1,20 -,39 2 KERAMIK-BECHER „FRESH“ Formschön und mit frischen Farben, „Fresh“ ist der perfekte Becher, um beim Kunden den besten Eindruck zu hinterlassen. Spülmaschinengeeignet. Maße: Ø 8 x 12 cm W Werbedruck. Fläche: links oder rechts vom Henkel, 55 x 110 mm Preis/Stk.: ab 36 Stück 1,40 W Werbedruck. Fläche: rundum, 180 x 110 mm Preis/Stk.: ab 36 Stück 1,85 Jede weitere Druckfarbe -,55 Werkzeugkosten: 55,-/Farbe Ohne Werbedruck, im Einzelkarton 145 416 gelb 4,95 145 432 orange 4,95 145 457 rot 4,95 145 473 grün 4,95 145 490 blau 4,95 Für EinzeltasseWerbedruck, 145 408 gelb ab 2,99 145 424 orange ab 2,99 145 449 rot ab 2,99 145 465 grün ab 2,99 145 481 blau ab 2,99 3 BECHER „SPECTA“ Eleganter Becher aus Porzellan (Farbe weiß) bzw. aus Keramik (farbige Version), Unbedruckte Ware wird im bruchsicheren Einzelkarton geliefert. Maße: Ø 8,2 x 9,4 cm Füllmenge: 280 ml W Werbedruck. Fläche: links oder rechts vom Henkel, 55 x 35 mm Preis/Stk.: ab 72 Stück 1,10 W Werbedruck. Fläche: rundum, 180 x 35 mm Preis/Stk.: ab 72 Stück 1,30 Jede weitere Druckfarbe -,49 Werkzeugkosten: 55,-/Farbe Ohne Werbedruck im Einzelkarton 161 867 weiß 3,99 161 883 rot 3,99 161 906 gelb 3,99 161 922 orange 3,99 161 947 dunkelblau 3,99 161 963 schwarz 3,99 Für Werbedruck 161 859 weiß ab 1,95 161 875 rot ab 2,75 161 891 gelb ab 2,75 161 914 orange ab 2,75 161 939 dunkelblau ab 2,75 161 955 schwarz ab 2,75 2 „FRESH“KERAMIK-BECHER ab 2 99 3 „SPECTA“BECHER ab 1 95 STÜCKAB WEISSETASSE FARBIGETASSE DRUCK 1C Links/ Rechts v. HENKEL DRUCK RUNDUM1C WEITEREFARBE 722,953,95 1,10 1,30 -,49 144 2,85 3,75 1,05 1,25-,45 288 2,75 3,45 -,99 1,19 -,42 576 2,45 2,95 -,95 1,09 -,39 1.152 1,95 2,75 -,85 -,99 -,35 STÜCKAB STÜCKPREIS DRUCK 1C Links/ Rechts vom HENKEL DRUCK RUNDUM1C WEITEREFARBE 364,99 1,40 1,85 -,55 72 4,69 1,30 1,75 -,49 144 4,29 1,20 1,70 -,46 288 3,99 1,10 1,60 -,45 5763,79 -,95 1,45 -,42 1.152 3,49 -,85 1,30 -,39 2.304 2,99 -,75 1,10 -,35




























































































137WERBEIDEEN | IHREIHRWERBUNGBECHER 3 BECHER „MODERN“ ab 3 95 STÜCKAB STÜCK-PREIS 1.DRUCKFARBE DRUCK RUNDUM1C WEITEREFARBE 36 4,75 1,45 1,90 -,55 72 4,55 1,35 1,80 -,49 144 4,35 1,25 1,70 -,46 288 4,25 1,19 1,60 -,45 576 4,15 1,09 1,45 -,42 1.152 3,95 -,99 1,30 -,39 2 PORZELLAN-TASSE „MIRA“ Porzellan-Tasse mit Henkel in klassischer Form. Maße: Ø 7 x 10 cm Füllmenge: ca. 200 ml W Werbedruck. Fläche: 142 x 73 mm, spülmaschinengeeignet Preis/Stk.: ab 72 Stück für die erste Druckfarbe 2,40 für jede weitere Farbe -,49 Einmalige Werkzeugkosten pro Farbe: 55,Ohne Werbedruck, im Einzelkarton 091 049 2,45 Für Werbedruck, Einzeltasse 091 065 ab 1,79 STÜCKAB STÜCK-PREIS 1.DRUCKFARBE WEITEREFARBE 72 2,29 2,40 -,49 288 2,19 1,60 -,45 5761,99 1,30 -,42 1.152 1,79 1,20 -,39 3 BECHER „MODERN“ Die gerade Form dieser Keramiktasse (350 ml) bietet besonders viel Platz für Ihre Werbebotschaft, die auf der matt weißen Fläche besonders gut zur Geltung kommt. Einen schönen Kontrast stellt die farbig glänzende Innenseite dar. Maße: 8,7 x Ø 9 cm W Fläche:Werbedruck. links oder rechts vom Henkel, 80 x 60 mm Preis/Stk.: ab 36 Stück 1,45 W Werbedruck. Fläche: rundum 225 x 60 mm Preis/Stk.: ab 36 Stück 1,90 jede weitere Druckfarbe: -,55 Werkzeugkosten pro Farbe: 55,für Werbedruck 204 850 weiß ab 3,95 204 868 orange ab 3,95 204 876 rot ab 3,95 204 884 hellgrün ab 3,95 204 892 reflexblau ab 3,95 204 905 schwarz ab 3,95 ohne Werbedruck, im Einzelkarton 204 913 weiß 5,45 204 921 orange 5,45 204 930 rot 5,45 204 948 hellgrün 5,45 204 956 reflexblau 5,45 204 964 schwarz 5,45 3 TASSE „HANDY“ COOL GRAU Absolut im Trend ist diese hochwertige Keramiktasse in mattem Grau, bei der das weiße Innere einen schönen Kontrast bildet. Maße: Ø 9 x 8,5 cm D Direktdruck. Fläche: 210 x 23 mm rundum Preis/Stk.: ab 36 Stück 1,90 W Werdedruck. Fläche: 65 x 23 mm links oder rechts vom Henkel Preis/Stk.: ab 36 Stück 1,45 jede weitere Druckarbe -,55 Werkzeugkosten pro Farbe: 55,ohne Werbedruck 196 303 grau 4,95 für Werbedruck 196 299 grau ab 2,75 3 TASSE „HANDY“ COOL GRAU ab 2 75 STÜCKAB STÜCK-PREIS 1.DRUCKFARBE DRUCK RUNDUM1C WEITEREFARBE 36 3,99 1,45 1,90 -,55 72 3,80 1,35 1,80 -,49 144 3,50 1,25 1,70 -,46 288 3,30 1,19 1,60 -,45 576 3,- 1,09 1,45 -,42 1.152 2,75 -,99 1,30 -,39 2 PORZELLANTASSE „MIRA“ ab 1 79










































Lieferung nur für den gewerblichen Bedarf. Alle Preise zzgl. MwSt.138 | WERBEIDEEN 1 „HANDYKERAMIK-BECHERSUPREME“ SCHWARZ Außen mattschwarz – innen hochglänzend. Diese stylischen Keramik-Becher bieten Ihnen beste Möglichkeiten mit Ihrem Logo auf dem Tisch Ihrer Kunden zu landen. Unbedruckte Ware wird im bruchsicheren Einzelkarton geliefert. Spühlmaschinengeeignet. Füllmenge: 300 ml Maße: 12 x Ø 9 cm W Werbedruck. Fläche: links oder rechts vom Henkel: 65 x 45 mm Preis/Stk.: ab 36 Stück 1,45 W Werbedruck. Fläche: rundum 230 x 40 mm Preis/Stk.: ab 36 Stück 1,90 Jede weitere Druckfarbe: -,55 Werkzeugkosten pro Farbe: 55,Ohne Werbedruck 164 652 blau 4,95 164 677 weiß 4,95 164 693 orange 4,95 164 716 grün 4,95 164 732 gelb 4,95 178 147 rot 4,95 Für Werbedruck 164 669 blau ab 3,15 164 685 weiß ab 3,15 164 708 orange ab 3,15 164 724 grün ab 3,15 164 749 gelb ab 3,15 166 412 rot ab 3,15 1 „HANDYKERAMIK-BECHERSUPREME“ ab 3 15 STÜCKAB STÜCK-PREIS 1.DRUCKFARBE DRUCK RUNDUM1C WEITEREFARBE 36 4,65 1,45 1,90 -,55 72 4,45 1,35 1,80 -,49 144 4,10 1,25 1,70 -,46 288 3,95 1,19 1,60 -,45 576 3,45 1,09 1,45 -,42 1.152 3,15 -,99 1,30 -,39 2 KAFFEEBECHER „HANDY PURE“, INNEN FARBIG Ob ein- oder zweifarbig, mit oder ohne Werbeanbringung – dieser Keramikbecher überzeugt nicht nur durch seine vielfältigen Farbvarianten mit innen hochglänzendem und außen mattem Finish, sondern auch durch seine hohe Qualität. Spülmaschinengeeignet. Maße: Ø 9 x 8,5 cm. Füllmenge: 310 ml W Werbedruck. Fläche: links oder rechts vom Henkel, 65 x 45 mm Preis/Stk.: ab 36 Stück 1,45 W Werbedruck. Fläche: 230 x 40 mm Preis/Stk.: ab 36 Stück 1,90 jede weitere Druckfarbe: -,55 Werkzeugkosten pro Farbe: 55,ohne Werbedruck 177 066 weiß 4,95 177 074 gelb 4,95 177 082 grün 4,95 177 103 rot 4,95 177 111 blau 4,95 für Werbedruck 177 120 weiß ab 3,15 177 138 gelb ab 3,15 177 146 grün ab 3,15 177 162 rot ab 3,15 177 179 blau ab 3,15 STÜCKAB STÜCK-PREIS 1.DRUCKFARBE DRUCK RUNDUM1C WEITEREFARBE 36 4,65 1,45 1,90 -,55 72 4,45 1,35 1,80 -,49 144 4,10 1,25 1,70 -,46 288 3,95 1,19 1,60 -,45 576 3,45 1,09 1,45 -,42 1.152 3,15 -,99 1,30 -,39 2 „HANDYKAFFEEBECHERPURE“ ab 3 15































































































farbigeweißerKeramikBecherBecherPorzellan 139WERBEIDEEN | 1 „HANDY“KAFFEEBECHER ab 2 89 2 BECHER „BAFY“ Diese klassische Porzellantasse bietet Ihnen besonders effektvolle Veredelungsmöglichkeiten: Dank Lasergravur erscheint Ihr Firmenlogo oder ein individueller Name in der Farbe der Innenwände. Spülmaschinengeeignet. Inhalt: 350 ml L Lasergravur. Fläche: 45 x 80 mm Preis/Stk.: ab 36 Stück 1,25 Werkzeugkosten: Siehe Serviceseiten. 186 213 pink ab 2,45 186 221 rot ab 2,45 186 230 gelb ab 2,45 186 248 orange ab 2,45 186 256 grün ab 2,45 STÜCKAB STÜCK-PREIS GRAVURLASER 1 4,65 36 4,35 1,25 108 4,15 1,15 432 3,85 1,1.296 3,35 -,90 2.592 2,95 -,80 5.184 2,45 -,65 2 BECHER„BAFY“ ab 2 45 1 KAFFEEBECHER „HANDY“ innen weiss Tassen zählen zu den beliebtesten Werbegeschenken –und das aus gutem Grund! Sie sind jahrelang im Einsatz, ohne dass sie ihre Wirkung verlieren. Nutzen Sie diesen Langzeiteffekt und zeigen Sie mit Ihrer Botschaft Präsenz auf diesen formschönen Tassen in unterschiedlichen Farbvarianten. Spülmaschinengeeignet. Maße: Ø 9 x 8,5 cm. Füllmenge: 300 ml W Werbedruck. Fläche: links oder rechts vom Henkel, 65 x 45 mm Preis/Stk.: ab 36 Stück 1,45 W Werbedruck. Fläche: rundum, 230 x 40 mm Preis/Stk.: ab 36 Stück 1,90 jede weitere Druckfarbe: -,55 Werkzeugkosten pro Farbe: 55,ohne Werbedruck 177 187 weiß 4,95 177 195 schwarz 4,95 177 200 rot 4,95 177 226 blau 4,95 für Werbedruck 177 234 weiß ab 2,89 177 242 schwarz ab 2,89 177 259 rot ab 2,89 177 275 blau ab 2,89 STÜCKAB STÜCK-PREIS 1.DRUCKFARBE DRUCK RUNDUM1C WEITEREFARBE 36 4,40 1,451,90 -,55 724,20 1,351,80 -,49 1443,95 1,251,70 -,46 2883,45 1,19 1,60 -,45 5763,20 1,091,45 -,42 1.1522,89 -,99 1,30 -,39









































































Innen Kunststoff doppelwandige Becher für heiße Getränke Lieferung nur für den gewerblichen Bedarf. Alle Preise zzgl. MwSt.140 | WERBEIDEEN 1 „COFFEE TO GO“ BECHER 350 ml Umweltschonend und stylisch: In dem doppelwandigen Kaffeebecher aus Kunststoff mit Schraubdeckel bleiben Heißgetränke auch unterwegs in perfekter Trinktemperatur. Spülmaschinengeeignet. BPA-frei. Maße: Ø 9 x 13 cm W Werbedruck. Fläche: 60 x 20 mm Preis/Stk.: ab 50 Stück -,85 S Siebdruck. Fläche: 200 x 40 mm Preis/Stk.: ab 50 Stück -,85 Werkzeugkosten: Siehe Serviceseiten. 179 393 blau ab 1,95 179 408 rot ab 1,95 179 424 grau ab 1,95 STÜCKAB STÜCK-PREIS 1.DRUCKFARBE 1 3,95 50 3,45 -,85 100 3,25 -,65 300 2,95 -,50 1.000 2,75 -,40 5.000 2,45 -,35 10.000 1,95 -,25 Druckkosten weitere Farben: siehe Onlineshop 1 „COFFEE TO GO“ BECHER ab 1 95 2 „GRANSOFTTOUCH-BECHER-TO-GOCAFÉ“ Wiederverwendbare To-go-Becher helfen nicht nur effektiv die Umwelt zu schützen, sondern bieten Ihnen zugleich besonders nachhaltige Werbemöglichkeiten – so wie auf diesem doppelwandigen Kunststoffbecher mit Softtouch-Oberfläche. Maße: Ø 9 x 17 cm Füllmenge: 500 ml S Siebdruck. Fläche: 160 x 45 mm rundum Preis/Stk.: ab 25 Stück 1,25 L Lasergravur. Fläche: 50 x 50 mm Preis/Stk.: ab 25 Stück 1,50 Werkzeugkosten: Siehe Serviceseiten. 198 292 rot ab 2,95 198 313 grün ab 2,95 STÜCKAB STÜCK-PREIS RUNDUM1.FARBE GRAVURLASER2515,454,95 1,251,50 504,45 1,15 1,40 150 4,25 1,-1,25 5003,95 -,80 1,05 1.000 3,45 -,55-,80 2.5002,95 -,45 -,70 Druckkosten weitere Farben: siehe Onlineshop 2 „GRANBECHER-TO-GOSOFTTOUCH-CAFÉ“ ab 2 95









































seiner
1.DRUCKFARBE 3015,455,15 1,25 100 4,85 1,10 250 4,55
500 3,95
1.500 3,49
Futuristisches Designobjekt mit praktischem Nutzen. Der doppelwandige Isolierbecher ist aus Kunststoff und Edelstahl, in den Schraubdeckel ist eine praktische Trinköffnung integriert. Perfekte Bodenhaftung dank gummiertem Standfuß. Maße: ca. Ø 7 x 21,5 cm Füllmenge: ca. 400 ml W Werbedruck. Fläche: 30 x 20 mm Preis/Stk.: ab 30 Stück 1,25 Werkzeugkosten: Siehe Serviceseiten schwarz ab 081 090 104 STÜCK-PREIS -,95 -,85 -,70 Farben: Onlineshop Verschluss aus Kunststoff mit Dichtung die Flasche auslaufsicher. Ø 6,6 17,5 cm Füllmenge: ca. 400 ml W Werbedruck. Fläche: 70 x 20 mm Preis/Stk.: ab 50 Stück -,75 Werkzeugkosten: Siehe Serviceseiten. -,75
siehe
x
hält
110 264 rot ab 1,79 110 272 blau ab 1,79 110 289 silber ab 1,79 2 TRINKFLASCHE MIT KARABINER ab1 79 STÜCKAB STÜCK-PREIS 1.DRUCKFARBE 1 2,69 50 2,49
3,49 171
100 2,29 -,65 300 1,99 -,60 1.000 1,89 -,50 2.000 1,79 -,40 Druckkosten weitere Farben: siehe Onlineshop 1 TRINKFLASCHEALUMINIUM „BIG TRANSIT“ ab 2 19 1 ALUMINIUM TRINKFLASCHE „BIG TRANSIT“ Diese formschöne Trinkflasche aus Aluminium mit Kunststoffverschluss hat einen farblich abgestimmten Karabinerhaken, mit dem sie ganz einfach an Rucksack & Co. befestigt werden kann. Füllmenge ca. 750 ml. Maße: Ø 7,2 x 25,5 cm S Siebdruck. Fläche: rundum 200 x 60 mm W Werbedruck. Fläche: 35 x 40 mm Preis/Stk.: ab 40 Stück 1,10 Werkzeugkosten: Siehe Serviceseiten. 190 190 schwarz ab 2,19 190 204 silber ab 2,19 190 212 blau ab 2,19 190 229 rot ab 2,19 190 237 grün ab 2,19 190 245 orange ab 2,19 STÜCKAB STÜCK-PREIS 1.DRUCKFARBE 1 3,75 40 3,35 1,10 100 3,25 -,95 250 3,15 -,90 500 2,85 -,80 1.000 2,65 -,65 2.000 2,35 -,45 5.000 2,19 -,40 Druckkosten weitere Farben: siehe Onlineshop 400 ml 750 ml
141WERBEIDEEN | DIE INNEREN WERTE ZÄHLEN 3
3 „EXCLUSIVEISOLIERBECHERLIQUID“ ab 3 49 2 MITTRINKFLASCHEKARABINER Trinkflasche aus lackiertem Metall, ideal für Kindergarten, Schule oder in der Freizeit. Durch den praktischen Karabinerhaken kann die Flasche an Ranzen oder Gürtel befestigt werden. Der
Maße:
blau ab 3,49 171
grau ab 3,49 171
„EXCLUSIVEISOLIERBECHERLIQUID“
171 073
Druckkosten weitere
rot ab 3,49 STÜCKAB























































































































Lieferung nur für den gewerblichen Bedarf. Alle Preise zzgl. MwSt.142 | WERBEIDEEN SCHLANK,ROBUST, TO GO 2 THERMOKANNE „ROBUSTA“ Ideal für den Genuss von Heiß- und Kaltgetränken auch unterwegs. Die doppelwandige Isolierkanne ist innen und außen aus Edelstahl und verfügt über einen komfortablen Ausgießer mit Schraubgewinde. Dank PushButton mit Feststellmöglichkeit ist der Verschluss besonders sicher. Maße: Ø 7 x 26 cm Füllmenge: 500 ml W Werbedruck. Fläche: 6 0 x 25 mm Preis/Stk.: ab 20 Stück 1,75 Werkzeugkosten: Siehe Serviceseiten. 177 347 schwarz ab 3,95 177 355 weiß ab 3,95 STÜCKAB STÜCK-PREIS 1.DRUCKFARBE 2016,956,75 1,75 100 5,95 1,50 250 5,45 1,25 500 4,95 1,1.500 3,95 -,60 Druckkosten weitere Farben: siehe Onlineshop 2 „ROBUSTA“THERMOKANNE ab 3 95 3 THERMOBECHER „SLIMLY“ Die schlanke Form macht diesen Thermobecher aus doppelwandigem Edelstahl zu einem besonders individuellen Werbegeschenk. Mit einem Schraubverschlussdeckel aus Kunststoff. Lieferung in Geschenkbox. Füllmenge ca. 250 ml. Maße: Ø 4,5 x 21 cm W Werbedruck. Fläche: seitlich 25 x 40 mm Preis/Stk: ab 20 Stück 1,50 S Siebdruck. Fläche: rundum 120 x 50 mm Preis/Stk: ab 20 Stück 1,90 Werkzeugkosten: Siehe Serviceseiten. 197 386 grau ab 4,29 197 409 türkis ab 4,29 197 492 weiß ab 4,29 197 417 rosa ab 4,29 STÜCKAB STÜCK-PREIS DRUCKSEITE RUNDUMDRUCK 2016,306,10 1,501,90 50 5,90 1,201,70 100 5,70 -,951,25 250 5,45 -,85-,95 500 4,70 -,60-,75 1.000 4,29 -,40-,60 Druckkosten weitere Farben: siehe Onlineshop 3 „SLIMLY“THERMOBECHER ab 4 29 1 IMTHERMOBECHER„FROSTY-LOOK“ Doppelwandiger 400 ml Trinkbecher. Innenteil aus schwarzem Kunststoff. Außenteil der Farben rot und blau aus transparenten Kunststoff. Die Farbe weiss ist vollfarben. Deckel als Schraubverschluss mit verschließbarer Trinköffnung. Deckel, Griff und Boden in schwarzem Kunststoff. Der Becher ist nicht spülmaschinengeeignet. Lieferung im Geschenkkarton. Maße: geschlossen ca. Ø 8 x 17 cm W Werbedruck. Fläche: ca. 40 x 30 mm Preis/Stk.: ab 50 Stück -,95 Werkzeugkosten: Siehe Serviceseiten. 083 346 blau transparent ab 2,19 083 354 rot transparent ab 2,19 083 362 weiß ab 2,19 STÜCKAB STÜCK-PREIS 1.DRUCKFARBE 5013,353,05 -,95 200 2,95 -,85 500 2,65 -,75 1.000 2,35 -,70 2.000 2,19 -,65 Druckkosten weitere Farben: siehe Onlineshop 1 „FROSTYTHERMOBECHERLOOK“ ab2 19














































































EFFEKTVOLL WERBEN MIT DIESEN SCHICKEN TRINKGEFÄSSEN 143WERBEIDEEN | 1 ALUMINIUM TRINKFLASCHE „FANCY“ Diese schicke einwandige Aluminium Trinkflasche punktet durch den silbernen Deckel mit sicherem Schraubverschluss Füllmenge: ca. 500 ml Maße: Ø 6,5 x 22 cm W Werbedruck. Fläche: 35 x 40 mm seitlich Preis/Stk.: ab 40 Stück -,95 S Siebdruck. Fläche: 180 x 50 mm rundum Preis/Stk.: ab 40 Stück 1,30 L Lasergravur. Fläche: 50 x 70 mm seitlich Preis/Stk.: ab 40 Stück 1,70 Werkzeugkosten: Siehe Serviceseiten. 207 018 schwarz/silber ab 2,29 207 026 weiß/silber ab 2,29 207 067 orange/orange ab 2,29 207 034 blau/silber ab 2,29 207 042 rot/silber ab 2,29 207 059 grün/silber ab 2,29 STÜCKAB STÜCK-PREIS 1.DRUCKFARBE DRUCKSIEB- GRAVURLASER4013,653,35 -,951,301,70 100 3,25 -,85 1,201,50 250 3,10 -,751,051,30 500 2,65 -,50-,85 1,10 2.000 2,29 -,35-,50-,75 Druckkosten weitere Farben: siehe Onlineshop 1 ALUMINIUM „FANCY“TRINKFLASCHE ab 2 29 2 METMAXX THERMOBECHER „OFFICE CUP AROMA“ Idealer Office-Becher in modernem Edge-Design, doppelwandig ohne Vakuum. Die kompakte Bauform passt unter jede Kaffeemaschine. Mit auslaufhemmendem Schiebeverschluss. LFGB-konform, Füllmenge 300ml. Material: Metall / Kunststoff Maße: 8,4 x Ø 12,4 cm L Lasergravur. Fläche: seitlich 55 x 15 mm Preis/Stk.: ab 25 Stück 1,80 W Werbedruck. Fläche: rundum 200 x 25 mm Preis/Stk.: ab 25 Stück 1,45 Werkzeugkosten: siehe Serviceseiten 206 058 schwarz ab 3,95 206 066 blau ab 3,95 206 074 rot ab 3,95 206 082 grün ab 3,95 206 099 orange ab 3,95 206 103 silber ab 3,95 STÜCKAB STÜCK-PREIS DRUCK RUNDUM1C GRAVURLASER1 6,25 25 5,95 1,45 1,80 50 5,85 1,20 1,60 150 5,65 -,95 1,20 300 5,35 -,75 -,95 500 4,85 -,50 -,70 1.000 3,95 -,30 -,60 2 METMAXX THERMOBECHER „OFFICE CUP AROMA“ ab 3 95






























































































OPTIMALE BEGLEITERLieferungnurfürden gewerblichen Bedarf. Alle Preise zzgl. MwSt.144 | WERBEIDEEN 2 ALUMINIUM COFFEE TO GO BECHER ab 2 45 1 „ST.ISOLIERBECHERPETERSBURG“ Mit diesem 450-Mililiter-Isolierbecher genießen Sie auch unterwegs Ihre Lieblingsgetränke in der optimalen Trinktemperatur. In den abnehmbaren Schraubdeckel mit Überlaufschutz ist ein praktischer Einhand-Klick-Verschluss integriert. Aus Edelstahl und Kunststoff. Maße: 8 x 19,8 x 8 cm W Werbedruck. Fläche: 70 x 20 mm Preis/Stk.: ab 20 Stück 1,50 L Lasergravur. Fläche: silberner Becher: 30 x 18 mm Preis/Stk.: ab 20 Stück 1,80 Werkzeugkosten: siehe Serviceseiten. 160 807 schwarz ab 3,95 160 815 silber ab 3,95 160 823 rot ab 3,95 160 831 grün ab 3,95 162 101 blau ab 3,95 161 795 weiß ab 3,95 1 ISOLIERBECHER „ST. PETERSBURG“ ab 3 95 STÜCKAB STÜCK-PREIS 1.DRUCKFARBE GRAVURLASER2017,156,65 1,501,80 50 6,15 1,251,40 100 5,45 1,101,20 250 4,95 -,951,05 400 3,95 -,80-,95 Druckkosten weitere Farben: siehe Onlineshop 2 COFFEEALUMINIUMTOGO BECHER Mehrweg statt Einweg. Dieser doppelwandige Coffee to go Becher aus Kunststoff mit Aluminiumhülle und praktischem Schiebeverschluss hält Getränke auch unterwegs lange warm und kann immer wieder verwendet werden. Maße: Ø 8,5 x 19 cm L Lasergravur. Fläche: 40 x 25 mm Preis/Stk.: ab 35 Stück 1,25 Werkzeugkosten: Siehe Serviceseiten. 187 431 dunkelblau ab 2,45 187 440 rot ab 2,45 187 466 grün ab 2,45 187 485 schwarz ab 2,45 STÜCKAB STÜCK-PREIS GRAVURLASER3514,454,15 1,25 1003,95 1,10 250 3,70 1,05 5003,30 -,90 1.000 2,95 -,70 2.500 2,45 -,45






























































































2 ISOLIERBECHER „TRAVEL“ Der doppelwandige Isolierbecher –innen aus Edelstahl und außen aus Kunststoff mit Gummimanschette – hält Ihre Getränke nicht nur warm, sondern lässt sich dank Quickstop Kunststoff-Trinkdeckel auch ganz bequem mit nur einer Hand bedienen. Maße: Ø 7 x 20,5 cm Füllmenge: 350 ml L Lasergravur. Fläche: 40 x 25 mm Preis/Stk.: ab 20 Stück 1,80 Werkzeugkosten: siehe Serviceseiten. 150 756 grün ab 5,19 150 764 blau ab 5,19 150 772 rot ab 5,19 150 789 pink ab 5,19 2 ISOLIERBECHER „TRAVEL“ ab 5 19 STÜCKAB STÜCK-PREIS GRAVURLASER2017,957,55 1,80 1007,25 1,20 200 6,65 -,85 4006,35 -,75 1.000 5,19 -,70 145WERBEIDEEN | TOUCHSOFT 1 THERMOKANNE „TRAVEL“ Diese doppelwandige Thermokanne aus Edelstahl verfügt dank SofttouchOberfläche über beste Griffeigenschaften. Mit Quickstop-Verschluss. Nur für Handspülung geeignet. Füllmenge: 500 ml Maße: Ø 8 x 24 cm W Werbedruck. Fläche: Vorne 25 x 30 mm Preis/Stk.: ab 12 Stück 2,80 S Siebdruck. Fläche: Rundum 170 x 50 mm Preis/Stk.: ab 12 Stück 2,80 Werkzeugkosten: Siehe Serviceseiten. 194 607 schwarz ab 9,95 194 615 rot ab 9,95 194 623 grün ab 9,95 194 631 blau ab 9,95 STÜCKAB STÜCK-PREIS 1.DRUCKFARBE 1 13,95 10 12,95 2,80 30 12,45 2,20 100 11,95 1,75 200 10,95 1,20 300 9,95 -,95 Druckkosten weitere Farben: siehe Onlineshop 1 THERMOKANNE „TRAVEL“ ab 9 95


















































MADE GERMANYIN 1 GLAS „ELEGANT-DRINK“TRINKFLASCHE Elegante Glas-Trinkflasche mit EdelschütztDiestahl/Kunststoff-SchraubverschlussbunteKunststoff-UmmantelungdieGeschmacks-undGeruchsneutrale Glasflasche vor Stößen und Brüchen. Spülmaschinengeeignet. Füllmenge: ca. 450 ml Maße: Ø 6,5 x 21 cm W Werbedruck. Fläche: auf Vorderseite 20 x 70 mm Preis/Stk.: ab 50 Stück -,85 S Siebdruck. Fläche: auf Vorderseite 150 x 50 mm Preis/Stk.: ab 50 Stück -,85 Werkzeugkosten: Siehe Serviceseiten. 220 201 magenta ab 1,59 220 210 grün ab 1,59 220 228 blau ab 1,59 STÜCKAB STÜCKPREIS 1.DRUCKFARBE 1 2,95 50 2,65 -,85 100 2,45 -,75 250 2,15 -,65 500 1,95 -,55 1.000 1,75 -,45 2.500 1,59 -,35 Druckkosten weitere Farben: siehe Onlineshop 1 GLAS TRINKFLASCHE „ELEGANT DRINK“ ab 1 59 STÜCKAB STÜCK-PREIS 1.DRUCKFARBE RUNDUM1.FARBE JEDEFARBEWEITERE 36 7,25 1,55 1,85 -,49 72 7,05 1,45 1,75 -,49 288 6,55 1,35 1,65 -,49 576 6,25 1,25 1,55 -,49 1.152 5,39 1,15 1,25 -,49 2 COFFEE TO PORZELLANBECHERGO ab 5 39 2 COFFEE TO „FREEDOM“PORZELLANBECHERGO300ML, WEISS Innen heiß, außen angenehm kühl! In diesem doppelwandigen Porzellanbecher bleiben Ihre Heißgetränke länger warm ohne dass Sie sich beim Tragen die Finger verbrennen. Mit Silikondeckel und attraktiven Veredelungsmöglichkeiten durch Spülmaschinengeeignet.Rundumdruck. Maße: Ø 9 cm x 14,8 cm Füllmenge: 300 ml W Werbedruck. Fläch e: 205 x 35 Preis/Stk.:mmab 36 Stück 1,55 T Transferdruck. Fläche: 190 x 120 mm, vollflächig Preis/Stk.: ab 36 Stück 1,85 jede weitere Druckfarbe/Stück: -,49 Einmalige Werkzeugkosten: 55,-/Farbe 177 040 ohne Druck 7,95 177 058 mit Druck ab 5,39 Lieferung nur für den gewerblichen Bedarf. Alle Preise zzgl. MwSt.146 | WERBEIDEEN







































passt Kaffeeautomatenunter KarabinergriffInnovativer 147WERBEIDEEN | 1 ISOLIERBECHER „TAKE FAST“ ab 2 59 1 ISOLIERBECHER „TAKE FAST“ Die nachhaltige Alternative zum klassischen Einweg-Becher. Der doppelwandige Isolierbecher ist außen aus Edelstahl und innen aus Kunststoff und wird mit einem Kunststoffdeckel mit integrierter Trinköffnung verschlossen. Mit gummiertem Standfuß für beste Bodenhaftung. Maße: Ø 7 x 14 cm Füllmenge: 290 ml W Werbedruck. Fläche: rundum: 50 x 200 mm Preis/Stk.: ab 40 Stück 1,05 Werkzeugkosten: Siehe Serviceseiten. 165 661 blau ab 2,59 165 670 rot ab 2,59 165 688 silber ab 2,59 165 696 schwarz ab 2,59 165 707 grün ab 2,59 STÜCKAB STÜCK-PREIS 1.DRUCKFARBE 4013,953,75 1,05 150 3,45 -,95 400 3,10 -,85 800 2,85 -,75 1.500 2,59 -,65 Druckkosten weitere Farben: siehe Onlineshop 3 KAFFEEBECHER „MEDANO“ Doppelwandiger Kaffeebecher, der unter fast jede Kaffeemaschine und in fast jede Autofassung passt. Außen aus Edelstahl und innen aus Kunststoff hält er durch die integrierte Silikondichtung im Deckel das Getränk dort wo es bleiben soll. Die Nase am Deckel ermöglicht ein einfaches öffnen. Maße: Ø 8,5 x 10 cm, Füllmenge: 250 ml W Werbedruck. Fläche: 25 x 40 mm Preis/Stk.: ab 25 Stück 1,40 L Lasergravur. Fläche: 30 x 60 mm Preis/Stk.: ab 25 Stück 1,80 Werkzeugkosten: Siehe Serviceseiten. 188 555 blau ab 3,85 188 563 braun ab 3,85 188 571 rot ab 3,85 188 580 silber ab 3,85 STÜCKAB STÜCK-PREIS 1.DRUCKFARBE GRAVURLASER 2515,855,75 1,401,80 50 5,65 1,20 1,60 150 5,25 -,95 1,20 250 4,95 -,75 -,95 500 4,45 -,50 -,70 1.000 3,85 -,45 -,60 Druckkosten weitere Farben: siehe Onlineshop 3 „MEDANO“KAFFEEBECHER ab 3 85 2 EDELSTAHL BECHER „HIKING DAY“ ab 2 29 2 EDELSTAHL BECHER „HIKING DAY“ Ideal für Wanderungen, Reisen, Camping & Co. sind diese leichten Becher mit innovativem Karabinergriff. Aus doppelwandigem, matt gebürstetem Edelstahl für heiße und kalte Getränke. Maße: Ø 7 x 8 cm, Füllmenge: 220 ml W Werbedruck. Fläche: 15 x 40 mm Preis/Stk: ab 40 Stück -,85 L Lasergravur. Fläche: 20 x 50 mm Preis/Stk: ab 40 Stück 1,10 Werkzeugkosten: Siehe Serviceseiten. 196 395 schwarz ab 2,29 196 400 blau ab 2,29 196 418 grün ab 2,29 196 426 rot ab 2,29 196 434 orange ab 2,29 STÜCKAB STÜCK-PREIS 1.DRUCKFARBE GRAVURLASER1 3,39–40 3,19 -,851,10 100 3,09 -,75-,95 250 2,99 -,50-,70 500 2,89 -,40-,60 1.000 2,59 -30-,50 3.000 2,29 -,20-,40 Druckkosten weitere Farben: siehe Onlineshop



















































































Edelstahl mit farblich abgesetztem Schraubverschluss und gummierter Manschette. In den Kunststoffdeckel ist eine Trinköffnung integriert. Der gummierte Standfuß sorgt für gute Bodenhaftung. Maße: ca. Ø 7 x 19,5 cm Füllmenge: ca. 400 ml W Werbedruck. Fläche: 50 x 25 mm Preis/Stk.: ab 20 Stück 1,30 S Siebdruck. Fläche: rundum, 150 x 25 mm Preis/Stk.: ab 20 Stück 1,30 Werkzeugkosten: Siehe Serviceseiten 171 049 blau ab 4,19 171 057 rot ab 4,19 171 065 grün ab 4,19 188 145 grau ab 4,19 1 „DARKISOLIERBECHERCREMA“ ab 4 19 Preisstaffel für Pos. 1+2
141 245
2 ISOLIERBECHER „CREMA“ Genießen Sie Ihr Lieblingsgetränk nicht nur zu Hause, sondern auch auf dem Weg ins Büro. In dem schlanken Isolierbecher aus Edelstahl mit Kunststoffgehäuse bleiben Ihre Getränke nicht nur warm, sondern laufen dank Kunststoffschraubverschluss mit Silikondichtung auch garantiert nicht aus. Maße: Ø 7 x 19,5 cm Füllmenge: 400 ml W Werbedruck. Fläche: 50 x 25 mm Preis/Stk.: ab 20 Stück 1,30 S Siebdruck. Fläche: rundum, 150 x 25 mm Preis/Stk.: ab 20 Stück 1,30 Werkzeugkosten: Siehe Serviceseiten blau schwarz
tropfsicherer Deckel mit Silikondichtung Lieferung nur für den gewerblichen Bedarf. Alle Preise zzgl. MwSt.148 | WERBEIDEEN ISOLIERBECHERTOGO MIT STIL
ab 4,19 141 253 orange ab 4,19 141 261
ab 4,19 141 270 grün ab 4,19 2 ISOLIER „CREMA“BECHER ab 4 19 STÜCKAB STÜCK-PREIS 1.DRUCKFARBE 1 6,25 20 5,95 1,30 100 5,55 -,90 500 4,95 -,70 1.000 4,45 -,55 2.000 4,19 -,45 Druckkosten weitere Farben: siehe Onlineshop
1 ISOLIERBECHER „DARK CREMA“ Black Beauty – der elegante Isolierbecher aus doppelwandigem





































































BA C D H GFE 10% FRUCHTGEHALT 149WERBEIDEEN | 2 HARIBO KOFFER-BLECHDOSE Ein Koffer voller Gummibärchen oder Cola-Fläschchen von Haribo – wer kann da widerstehen. Nach Verzehr ist der Metallkoffer auch als Brotdose noch bestens verwendbar. Maße: 12 x 9 x 3,5 cm Inhalt: je 150 g W Werbedruck. Fläche: 45 x 40 mm Preis/Stk.: ab 40 Stück -,85 Werkzeugkosten: siehe Serviceseiten. 158 839 Gummibärchen ab 2,79 158 847 Cola-Fläschchen ab 2,79 2 HARIBO BLECHDOSEKOFFERab 2 79 STÜCKAB STÜCK-PREIS 1.DRUCKFARBE 4013,753,55 -,85 100 3,35 -,80 250 3,20 -,75 500 2,95 -,70 1.5002,79 -,60 Druckkosten weitere Farben: siehe Onlineshop 3 FRUCHTGUMMITÜTEN INDIVIDUELL ab 0 16 3 INDIVIDUELLFRUCHTGUMMITÜTEN A Gefällt mir B Auto C LKW D Kleeblatt E Blume F Handy G Herz H Smiley I Werkzeug J Bärchen Ob Herzen oder Blumen, Autos oder LKWs, verschiedene Werkzeuge, Handys, Kleeblätter, ausgestreckte „Gefällt mir“ Daumen oder klassische Bärchen –wählen Sie je nach Anlass die passende Fruchtgummi-Form. Selbstverständlich können Sie auch die Verpackung individuell und komplett bedrucken – und das bereits ab 3.500 Stück! Maße: 85 x 65 mm Inhalt: 10 g je Tüte Die Tüte ist vollfl ächig bedruckbar in 4C. Keine weiteren Werkzeugkosten. 153 150 ab -,16 STÜCKAB PREIS1C PREIS2C PREIS3C PREIS4C PREIS5C 3.500 -,27 -,34 -,38 -,44-,49 5.000 -,23 -,28 -,33-,36-,39 10.000 -,16-,19-,21 -,24-,26 MADE GERMANYIN 1 HOMEOFFICE MOTIVATIONSHAUS MIT KEKSEN Gute Laune im Homeoffice zu bewahren ist nicht immer einfach. Umso mehr freuen sich Ihre Mitarbeiter über kleine, aufmunternde Präsente. Die 5 MotivationsGlückskekse lenken den Blick mit weisen Sprüchen aufs Wesentliche, schenken Achtsamkeit und sorgen für ein kleines Lachen. Mit einer Motivationskarte für den Schreibtisch, gefertigt in Werkstätten für Menschen mit Behinderung. Maße: 9 x 9 x 17 cm 210 888 6,95 1 MOTIVATIONSHAUSHOMEOFFICE MIT KEKSEN 6 95 KEKSE5




























































































































DRUCK4C DRUCK4C DRUCK4C Lieferung nur für den gewerblichen Bedarf. Alle Preise zzgl. MwSt.150 | WERBEIDEEN
format bringen frischen Atem in Ihre Werbung. Große Werbefläche. Maße: ca. 7,5 x 4,5 x 0,5 cm W Werbedruck. Fläche: 60 x 35 mm Preis/Stk.: ab 250 Stück -,15 Werkzeugkosten: Siehe Serviceseiten. D Digitaldruck 4c. Fläche: 73 x 43 Preis/Stk.:mmab 250 Stück -,40 Datenhandling: einmalig 29,285 409 frosty blau ab -,33 285 417 frosty rot ab -,33 285 425 weiß ab -,33 3 HERZBONBON IN BLECHDOSE ab 0 59 1 MINT-SPENDER ab 0 29 4 MINTCARD ab 0 33 STÜCKAB STÜCK-PREIS DRUCK1C DIGITAL4C 1 -,49–250 -,44 -,15-,40 1.000 -,41 -,14-,38 2.500 -,39 -,13-,35 5.000 -,36 -,12-,30 10.000 -,33 -,10 -,26 Druckkosten weitere Farben: siehe Onlineshop STÜCKAB STÜCK-PREIS 1.DRUCKFARBE DIGITAL4C 3001-,45 -,39 -,15-,40 1.000 -,37 -,14 -,32 2.500 -,35 -,12-,28 10.000 -,33 -,11-,25 20.000 -,29 -,10-,20 Druckkosten weitere Farben: siehe Onlineshop STÜCKAB STÜCK-PREIS 1.DRUCKFARBE 1 -,79 150 -,76 -,25 300 -,73 -,22 1.000 -,69 -,18 2.500 -,64 -,16 10.000 -,59 -,14 Druckkosten weitere Farben: siehe Onlineshop 2 PFEFFERMINZDOSE „LIKE“ Besser können Sie Ihr Firmenlogo nicht präsentieren! Die „Gefällt mir“-Hand ist nicht nur ein besonders positiver Werbeträger, sondern zugleich mit leckeren Pfefferminzpastillen gefüllt. Maße: 6 x 8,5 x 0,5 cm W Werbedruck. Fläche: 30 x 20 mm Preis/Stk.: ab 200 Stück -,18 Werkzeugkosten: Siehe Serviceseiten. D Digitaldruck 4c. Fläche: 30 x 38 Preis/Stk.:mmab 200 Stück -,35 Datenhandling: einmalig 29,175 446 weiß ab -,45 175 454 blau ab -,45 175 462 rot ab -,45 2 PFEFFERMINZDOSE „LIKE“ ab 0 45 STÜCKAB STÜCK-PREIS 1.DRUCKFARBE DIGITAL4C 2001-,59-,56 -,18 -,35 1.000 -,52 -,16 -,30 2.500 -,49 -,14 -,28 5.000 -,45 -,12 -,25 Druckkosten weitere Farben: siehe Onlineshop
Ob zur Hochzeit, am Valentinstag oder als kleiner Dank zwischendurch – sagen Sie’s mit Herz! Die roten Metalldosen in Herzform sind bis zum Rand mit ebenfalls herzförmigen Bonbons gefüllt. Maße: 7 x 6 x 1,5 cm Inhalt: 27 g W Werbedruck. Fläche: 35 x 15 mm Preis/Stk.: ab 150 Stück -,25 Werkzeugkosten: siehe Serviceseiten. 158 822 ab -,59 50 zuckerfreie Pfefferminzpastillen in einer Kunststoffbox im Scheckkarten-
Klassische Mint-Spender in innovativen Formen: Ob als Herz, Auto- oder Haus – wählen Sie den Mint-Spender passend zu Anlass und Branche. Inhalt: je 8 g W Werbedruck. Fläche: Herz, 40 x 20 mm. Haus, 35 x 30 mm. Auto, 45 x 10 mm. Preis/Stk.: ab 300 Stück -,15 Werkzeugkosten: siehe Serviceseiten. D Digitaldruck 4c. Fläche: Herz, 40 x 20 mm. Haus, 35 x 30 mm. Auto, 45 x 10 mm. Preis/Stk.: ab 300 Stück -,40 Datenhandling: einmalig 29,158 791 Herz ab -,29 158 806 Haus ab -,29 158 814 Auto blau ab -,29 160 219 Auto weiß ab -,29
1 MINT-SPENDER
3 HERZBONBON BLECHDOSE
4 MINTCARD

2 PFEFFERMINZ CLICK-DOSE Metalldose mit magischem Pfefferminzdragees.mitKlack-VerschlussmechanismusKlick--gefülltatemerfrischenden,zuckerfreien Inhalt: 12 g Maße: Ø 4 x 1 cm W Werbedruck. Fläche: Ø 25 mm Preis/Stk.: ab 120 Stück -,26 Werkzeugkosten: Siehe Serviceseiten. D Digitaldruck 4c. Fläche: 40 x 40 Preis/Stk.:mmab 120 Stück -,50 Datenhandling: einmalig 29,134 447 silber ab -,85 134 455 blau ab -,85 134 463 weiss ab -,85 142 211 rot ab -,85 3 CHOCO-MIX CLICK-DOSE Die Metalldose mit dem verheißungsvollen Klicken. Im Inneren befinden sich kunterbunte Schokodragees, der runde Deckel bietet viel Raum für Ihre Werbebotschaft. Maße: Ø 4 x 1 cm W Werbedruck. Fläche:
4C-DIGITALDRUCKFOTOREALISTISCHER
clickclack NAUTIL US DRUCK4C DRUCK4C 151WERBEIDEEN |
Ø 25 mm Preis/Stk.: ab 200 Stück -,20 Werkzeugkosten: Siehe Serviceseiten. D Digitaldruck 4c. Fläche: 40 x 40 Preis/Stk.:mmab 200 Stück -,50 Datenhandling: einmalig 29,139 311 silber ab -,45 139 320 blau ab -,45 139 338 weiss ab -,45 139 346 rot ab -,45 1 METALLDOSE PFEFFERMINZ Da greift man gerne zu: Pfefferminzbonbons in eleganter Mattglanz-Blechdose. Maße: ca. 6 x 4,7 x 1,4 cm Inhalt: 19 g W Werbedruck. Fläche: 30 x 20 mm Preis/Stk.: ab 70 Stück -,47 Werkzeugkosten: Siehe Serviceseiten. 155 602 weiß ab 1,59 155 627 schwarz ab 1,59 111 722 silber ab 1,59 1 METALLDOSE PFEFFERMINZ ab 0 99 3 CLICK-DOSECHOCO-MIX ab 0 45 2 PFEFFERMINZ CLICK-DOSE ab 0 85 STÜCKAB STÜCK-PREIS 1.DRUCKFARBE DIGITAL4C 2001-,59-,56 -,20-,50 500 -,53 -,18-,45 1.500 -,51 -,17-,38 3.000 -,49 -,16-,35 10.000 -,45 -,14-,30 Druckkosten weitere Farben: siehe Onlineshop STÜCKAB STÜCK-PREIS 1.DRUCKFARBE DIGITAL4C 12011,151,05 -,26 -,50 250 -,99 -,23 -,45 1.000 -,92 -,20 -,42 3.000 -,89 -,18-,40 10.000 -,85 -,16-,35 Druckkosten weitere Farben: siehe Onlineshop STÜCKAB STÜCK-PREIS 1.DRUCKFARBE 7011,951,85 -,47 150 1,75 -,42 500 1,59 -,37 2.500 1,29 -,32 5.000 -,99 -,27 Druckkosten weitere Farben: siehe Onlineshop

































Metallplatte WerbeanbringungWerbeanbringungfür 2 BAMBUS TASCHENMESSER 9 Funktionen. Das Taschenmesser mit Weinflaschenöffner, Nagelfeile und -reiniger, kleiner Klinge, Dosenöffner, Bierflaschenöffner, Säge, Messerklinge und Schere ist nicht nur überaus nützlich, sondern besticht auch durch seine Oberfläche aus nachhaltigem Bambus. Maße: 9 x 2,5 x 1,8 cm W Werbedruck. Fläche: auf einer Seite 40 x 12 mm Preis/Stk.: ab 40 Stück L Lasergravur. Fläche: auf einer Seite 40 x 12 mm Preis/Stk.: ab 40 Stück Werkzeugkosten: Siehe Serviceseiten. 215 912 2 BAMBUS TASCHENMESSER 9 Funktionen. ab 1 95 STÜCKAB STÜCK-PREIS 1.DRUCKFARBE GRAVUR 1 3,55 40 3,25 -,80 100 2,95 -,70 250 2,75 -,60 500 2,45 -,50-,80 1.000 2,25 -,35-,60 2.000 1,95 -,20-,40 Druckkosten weitere Farben: siehe Onlineshop 9 FUNKTIONEN edleGeschenkbox STÜCKAB STÜCK-PREIS 1.DRUCKFARBE ÄTZUNG Druckkosten1.0004,95-,80-,955005,45-,951,202505,651,201,501505,801,401,70205,951,501,8016,35weitereFarben:sieheOnlineshop 1 11MITTASCHENMESSERHOLZGRIFF,FUNKTIONEN Mit diesem Präsent werden Sie Ihre guten Geschäftsfreunde oder Mitarbeiter überraschen: Hochwertiges Taschenmesser in edler Optik. 11 Teile, z.B. Öffner, Messer, Schraubendreher, Säge, Korkenzieher u.v.m. Schlüsselring. Eingelegt im eleganten Holzetui. Maße: Messer ca. 9 x 2,2 x 1,9 cm. Etui ca. 13 x 5 x 3 cm W Werbedruck. Fläche: Etui: 60 x 30 mm Preis/Stk.: ab 20 Stück 1,50 Ä Ätzung. Fläche: großen Klinge: ca. 20 x 4 mm Preis/Stk.: ab 20 Stück 1,80 Werkzeugkosten: Siehe Serviceseiten 273 569 ab 4,95 1 MITTASCHENMESSERHOLZGRIFF ab 4 95 20 TASCHENMESSER MIT inkl.HOLZGRIFFDruckauf Etui 286 022 169.-WERBETIPP* Lieferung nur für den gewerblichen Bedarf. Alle Preise zzgl. MwSt.152 | WERBEIDEEN 3 ALU-KOFFER GRILLBESTECKMIT ab 11 95 3 ALU-KOFFER MIT GRILLBESTECK Alu-Koffer mit 3-teiligem Grillbesteck. Damit kann die Grill-Saison beginnen. Grillwender, Fleischgabel und Würstchenzange aus massivem Edelstahl. Alle Teile zum Aufhängen. Befestigung in der Box mittels Klettverschluss. Koffer mit Griff und 2 stabilen Schnappverschlüssen. Aufgenietetes Edelstahlplättchen für die elegante Werbeanbringung. Maße: Koffer 37 x 10 x 8,5 cm L Lasergravur. Fläche: 50 x 20 mm Preis/Stk.: ab 10 Stück 3,45 Werkzeugkosten: Siehe Serviceseiten. 286 485 ab 11,95 STÜCKAB STÜCK-PREIS GRAVURLASER1016,45117,95 3,45 5015,95 2,95 10014,95 2,20 25013,95 1,80 50011,95 1,50




























































14 starke LEDs 4 MULTI-TOOL14-LED-LAMPE ab 15 95 TEILE2 STÜCKAB 10PREIScm 12PREIScm ÄTZUNG 25012,9515,951,9010013,4516,252,403013,9516,753,10814,4517,253,90114,9517,95 3 KLAPPTASCHENMESSERHERBERTZ Klinge aus rostfreiem Hochleistungsstahl. Heft aus Zinkdruckguss. Geschenkkarton. Ä Ätzung. Fläche: Klinge: 40 x 6 mm Preis/Stk.: ab 8 Stück 3,90 Werkzeugkosten: Siehe Serviceseiten. 053 149 Heftlänge 10 cm ab 12,95 053 157 Heftlänge 12 cm ab 15,95 3 HERBERTZ TASCHENMESSERKLAPPab 12 95 1 MULTITOOL PUMA TEC Große Vielfalt auf kleinstem Raum. Dieses wertige Multitool enthält neben einer Zange mit Drahtschneider auch Messer, Säge, Feile, Kreuzschlitzschraubendreher und Flaschenöffner und ist in einem praktischen Nylonetui mit Gürtelschlaufe verpackt. Material: AISI 420 Stahl, AluminiumGriffe, Epoxy-Beschichtung. Maße: Verpackung 16,5 x 15,5 x 6 cm L Laserbeschriftung. Fläche: auf Griff, 50 x 7 mm Preis/Stk.: ab 7 Stück 3,90 Werkzeugkosten: Siehe Serviceseiten. 178 448 ab 15,95 STÜCKAB STÜCK-PREIS GRAVURLASER7118,9517,95 3,90 15 17,75 3,60 50 16,95 3,20 100 15,95 2,95 1 PUMAMULTI-TOOLTEC ab 15 95 4 MULTITOOL MIT 14-LEDLAMPE Ob im Berufsalltag oder in der Freizeit – dieses Multitool mit Zange, Säge, Dosenöffner, Nagelpfeile, verschiedenen Schlitz- und Kreuzschraubendrehern sowie einem extra scharfen Messer rüstet Sie für alle Eventualitäten. Und das dank Metalltaschenlampe mit 14 LEDs auch bei Dunkelheit. Maße: 17,1 x 13 x 3,8 cm Hinweis: 3 AAA Batterien enthalten. W Werbedruck. Fläche: Etui, 100 x 30 mm Preis/Stk.: ab 7 Stück 3,95 L Laserbeschriftung. Fläche: auf Lampe, 30 x 10 mm. Oder dem Werkzeug, 40 x 5 mm Preis/Stk.: ab 7 Stück 4,50 Werkzeugkosten: Siehe Serviceseiten. 178 405 ab 15,95 STÜCKAB STÜCK-PREIS 1.DRUCKFARBE GRAVURLASER7118,9517,95 3,954,50 15 17,50 3,503,95 50 16,95 2,953,20 100 15,95 2,202,60 Druckkosten weitere Farben: siehe Onlineshop 153WERBEIDEEN | 2 MULTIFUNKTIONS„PLIERS“WERKZEUG ab 6 95 2 MULTIFUNKTIONSWERKZEUG„PLIERS“ Ein ganzes Werkzeugset im praktischen Hosentaschenformat! In den Aluminium beschichteten Griffen sind neun hochwertige Edelstahlwerkzeuge integriert. Inhalt: Säge, Feile, Dosenöffner, Kapselheber, Messerklinge, kleiner und großer Schraubendreher, Kreuzschlitzdreher, gefederte Kombizange. In einer Nylon-Tasche mit Klettverschluss und Gürtelschlaufe. SP Spezialsiebdruck. Fläche: Etui: big 25 x 18 mm Preis/Stk.: ab 15 Stück 1,95 Werkzeugkosten: Siehe Serviceseiten. 165 758 silber ab 6,95 165 766 blau ab 6,95 165 774 rot ab 6,95 STÜCKAB STÜCK-PREIS 1.DRUCKFARBE 1 8,95 15 8,75 1,95 50 8,45 1,45 1007,95 -,95 2507,35 ,-85 5006,95 -,75 Druckkosten weitere Farben: siehe Onlineshop














































































































ORIGINAL
3 SCHWEIZERVICTORINOXMESSER TOURIST 12 Funktionen 2 Klingen, 2 Schraubenzieher, Kapselheber, Dosenöffner, Korkenzieher, Ahle, Zahnstocher, Drahtabisolierer, Pinzette. Mit Ring. Heftlänge 8 cm. Einzelkarton. Ä Ätzung. Fläche: Klinge, 35 x 6 mm Preis/Stk.: ab 10 Stück -,95 W Werbedruck. Fläche: Schale, 40 x 11 Preis/Stk.:mmab 10 Stück -,95 Werkzeugkosten: Siehe Serviceseiten. 041 669 rot ab 16,95 186 922 weiß ab 16,95 186 939 schwarz ab 16,95 186 947 blau ab 16,95
2 SCHWEIZERVICTORINOXMESSER CAMPER 13 Funktionen
2
2 Klingen, 2 Schraubenzieher, Kapselheber, Dosenöffner, Drahtabisolierer, Korkenzieher, Säge, Ahle, Zahnstocher, Pinzette. Mit Ring. Heftlänge 9 cm. Einzelkarton. Ä Ätzung. Fläche: Klinge, 35 x 6 mm Preis/Stk.: ab 10 Stück -,95 Ä Werbedruck. Fläche: Schale, 45 x 13 Preis/Stk.:mmab 10 Stück -,95 Werkzeugkosten:
Siehe Serviceseiten. 041 708 rot ab 19,95 186 891 weiß ab 19,95 186 906 schwarz ab 19,95 186 914 blau ab 19,95 STÜCKAB STÜCK-PREIS 1.DRUCKFARBE ÄTZUNG 10124,9523,95 -,95-,95 25 22,95 -,90-,90 100 21,45 -,85-,85 250 19,95 -,75-,75 Druckkosten weitere Farben: siehe Onlineshop STÜCKAB STÜCK-PREIS 1.DRUCKFARBE ÄTZUNG 10120,9519,95 -,95-,95 25 19,45 -,90-,90 100 18,95 -,80-,80 250 16,95 -,70-,70 Druckkosten weitere Farben: siehe Onlineshop STÜCKAB STÜCK-PREIS 1.DRUCKFARBE ÄTZUNG 137,95 6 36,95 1,151,15 25 34,95 -,95-,90 100 32,95 -,80-,80 250 29,95 -,70-,70 Druckkosten weitere Farben: siehe Onlineshop 10 01413MESSERSCHWEIZERCAMPERFunktionen883rot 269.-WERBETIPP* 10 01412MESSERSCHWEIZERTOURISTFunktionen998rot 229.-WERBETIPP* 2 VICTORINOX SCHWEIZER MESSER, CAMPER ab 19 95 3 VICTORINOX SCHWEIZER MESSER TOURIST ab 16 95 1 VICTORINOX SCHWEIZER MESSER HUNTSMAN ab 29 95 Lieferung nur für den gewerblichen Bedarf. Alle Preise zzgl. MwSt.154 | WERBEIDEEN
1 VICTORINOX SCHWEIZER MESSER HUNTSMAN 15 Funktionen Klingen, 2 Schraubenzieher, Kapselheber, Dosenöffner, Korkenzieher, Ahle, Zahnstocher, Drahtabisolierer, Mehrzweckhaken, Pinzette, Schere, Säge. Mit Ring. Heftlänge 9 cm. Einzelkarton. Ä Ätzung. Fläche: Klinge, 40 x 7mm Preis/Stk.: ab 6 Stück 1,15 W Werbedruck. Fläche: Schale, 45 x 12 Preis/Stk.:mm ab 6 Stück 1,15 Werkzeugkosten: Siehe Serviceseiten. 041 677 rot ab 29,95 186 867 weiß ab 29,95 186 875 schwarz ab 29,95 186 883 blau ab 29,95




























ORIGINAL 7 FUNKTIONEN 9 FUNKTIONEN * Komplettpreis inklusiv einfarbigem, einseitigen Werbeaufdruck in Standardschrift DRUCK4C 8 FUNKTIONENDRUCKDRUCK4C4C 155WERBEIDEEN | 3 SCHWEIZERVICTORINOXMESSER BANTAM 8 Funktionen 2 Klingen/Dosenöffner, Schraubenzieher, Kapselheber, Zahnstocher, Pinzette. Drahtabisolierer, Mit Ring. Heftlänge 8 cm. Einzelkarton. Ä Ätzung. Fläche: Klinge: 35 x 6 mm Preis/Stk.: ab 10 Stück 1,80 W Werbedruck. Fläche: Schale: 40 x 11 mm Preis/Stk.: ab 10 Stück 1,80 Werkzeugkosten: Siehe Serviceseiten. D Digitaldruck 4c. Fläche: 70 x 12 Preis/Stk.:mmab 10 Stück 4,Datenhandling: einmalig 29,041 636 rot ab 9,95 178 106 weiß ab 9,95 178 114 schwarz ab 9,95 178 122 blau ab 9,95 2 SCHWEIZERVICTORINOXMESSER WAITER 9 Funktionen Klinge, Schraubenzieher, Kapselheber, Zahnstocher, Dosenöffner, Drahtabisolierer, Korkenzieher, Pinzette. Mit Ring. Heftlänge 8 cm. Einzelkarton. Ä Ätzung. Fläche: Klinge, 35 x 6 mm Preis/Stk.: ab 10 Stück 1,80 W Werbedruck. Fläche: Schale: 40 x 12 mm Preis/Stk.: ab 10 Stück 1,80 Werkzeugkosten: Siehe Serviceseiten. D Digitaldruck 4c. Fläche: 70 x 12 Preis/Stk.:mmab 10 Stück 4,Datenhandling: einmalig 29,041 644 rot ab 10,95 165 516 weiß ab 10,95 178 083 schwarz ab 10,95 178 091 blau ab 10,95 1 SCHWEIZERVICTORINOXMESSER CLASSIC 7 Funktionen Klinge, Nagelfeile/-reiniger, Schere, Zahnstocher, Pinzette. Schraubenzieher. Mit Ring. Heftlänge 6 cm. Einzelkarton. Ä Ätzung. Fläche: Klinge, 20 x 3 mm Preis/Stk.: ab 10 Stück 1,80 W Werbedruck. Fläche: Schale: 25 x 8 mm Preis/Stk.: ab 10 Stück 1,80 Werkzeugkosten: Siehe Serviceseiten. D Digitaldruck 4c. Fläche: 30 x 10 Preis/Stk.:mmab 10 Stück 4,Datenhandling: einmalig 29,041 610 rot ab 11,95 178 059 weiß ab 11,95 178 067 schwarz ab 11,95 178 075 blau ab 11,95 STK.AB STÜCK-PREIS 1.DRUCKFARBE ÄTZUNG DIGITAL4C 10116,9516,45 1,801,80 4,50 15,95 -,95-,952,20 100 14,45 -,80-,801,70 250 12,95 -,70-,701,40 500 11,95 -,60-,601,20 Druckkosten weitere Farben: siehe Onlineshop STK.AB STÜCK-PREIS 1.DRUCKFARBE ÄTZUNG DIGITAL4C 10114,9514,45 1,801,80 4,50 13,95 -,95-,952,20 100 13,45 -,80-,801,70 250 12,95 -,70-,701,40 500 10,95 -,60-,601,20 Druckkosten weitere Farben: siehe Onlineshop STK.AB STÜCK-PREIS 1.DRUCKFARBE ÄTZUNG DIGITAL4C 10114,4513,95 1,801,80 4,50 13,45 -,95-,952,20 100 12,95 -,80-,801,70 250 11,95 -,70-,701,40 500 9,95 -,60-,601,20 Druckkosten weitere Farben: siehe Onlineshop 3 SCHWEIZERVICTORINOX MESSER BANTAM ab 9 95 2 SCHWEIZERVICTORINOX MESSER WAITER ab 10 95 1 MESSERSCHWEIZERVICTORINOXCLASSIC ab 11 95

























Lieferung nur für den gewerblichen Bedarf. Alle Preise zzgl. MwSt.156 | WERBEIDEEN 1 SWISSCARD QUATTRO ab 13 95 DRUCK4C 2 ORIG. SWISSCARDVICTORINOXCLASSIC ab 21 95 3 VICTORINOX GESCHENK-SET 2 Messer 2 Original Schweizer Taschenmesser, siehe Artikel 041 669 und 041 610. Im Geschenkkarton. Maße: 13,5 x 7 x 3 cm Ä Ätzung: siehe Artikel 041 669 und 041 610 auf der Klinge Preis/Set: ab 6 Sets 3,95 W Werbedruck Fläche: Etui, 45 x 25 Preis/Ser:mmab 6 Sets 3,95 Werkzeugkosten: Siehe Serviceseiten. 041 601 ab 26,95 SETAB PREISSET- 1.DRUCKFARBE ÄTZUNG 129,95 6 29,45 3,953,95 25 28,95 2,952,95 50 27,95 1,951,95 100 26,95 1,401,40 Druckkosten weitere Farben: siehe Onlineshop 3 GESCHENK-SETVICTORINOX 2 MESSER ab 26 95 STÜCKAB STÜCK-PREIS 1.DRUCKFARBE DIGITAL4C 126,95 6 25,45 2,95 6,25 24,75 1,503,50 50 22,95 1,102,50 100 21,95 1,-1,95 Druckkosten weitere Farben: siehe Onlineshop 2 ORIGINAL SWISSCARDVICTORINOXCLASSIC Im Scheckkartenformat mit 10 Funktionen: Schere, Brieföffner, Nagelfeile, Schraubendreher, Maßstab, Kugelschreiber, Pinzette, Zahnstocher und Nadel. Maße: 8,1 x 5,3 x 0,3 cm W Werbedruck. Fläche: 50 x 25 mm Preis/Stk.: ab 6 Stück 2,95 Werkzeugkosten: Siehe Serviceseiten. D Digitaldruck 4c. Fläche: 50 x 25 Preis/Stk.:mm ab 6 Stück 6,Datenhandling: einmalig 29,178 042 ab 21,95 1 VICTORINOX SWISSCARD QUATTRO Ein ganzes Werkzeugset im Scheckkarten-Format! Neben einem Brieföffner sorgen fünf verschiedene Schraubendreher sowie Stecknadel, Nagelpfeile, Pinzette, Zahnstocher, Kugelschreiber und Maßstab dafür, dass Sie für alle Lebenslagen gewappnet sind. Ein echtes Qualitätsprodukt von Victorinox – dem Hersteller der original Schweizer Taschenmesser. Maße: 8,2 x 5,4 x 0,4 cm W Werbedruck. Fläche: 50 x 25 mm Preis/Stk.: ab 10 Stück 2,90 Werkzeugkosten: siehe Serviceseiten. D Digitaldruck 4c. Fläche: 50 x 25 mm Preis/Stk.: ab 10 Stück 6,Datenhandling: einmalig 29,161 762 rot ab 13,95 161 779 blau ab 13,95 161 787 anthrazit ab 13,95 STÜCKAB STÜCK-PREIS 1.DRUCKFARBE DIGITAL4C 10116,9516,45 2,90 6,25 15,95 1,503,50 100 15,45 1,-1,95 250 13,95 -,851,70 Druckkosten weitere Farben: siehe Onlineshop 2 MESSER DRUCK4C









































DRUCK4C Mit Magnet 157WERBEIDEEN | 1 MAXXMEE MAGNETARMBANDHEIMWERKER Das MAXXMEE Handwerker-Armband ist das Must-Have für alle, die sich ihre Hand- und Heimwerkerarbeiten einfach leichter machen möchten. Das Armband lässt sich per Klettverschluss individuell an Ihr Handgelenk anpassen. 15 starke Magnete im Armband halten zuverlässig Schrauben, Muttern, Bits, Unterlegscheiben etc. Für nichtmagnetische Gegenstände, z. B. aus Holz oder Kunststoff, besitzt das Armband zusätzlich zwei praktische Taschen. Aus langlebigem Material, leicht, atmungsaktiv und angenehm zu tragen. Verstellbarer Klettverschluss. Maße: 40 x 9,2 x 0,2 cm 214 578 6,95 1 MAXXMEE HEIMWERKER MAGNETARMBAND 6 95 2 SCHRAUBENDREHER-SET ab 3 49 2 SCHRAUBENDREHER-SET 26-teiliges Schraubendreher-Set, mit Schraubendreher und 24 verschiedenen Aufsätzen, die magnetisch an dem Stift haften und somit Schrauben praktisch anziehen. In handlicher Box mit Pushbutton OPEN/CLOSE Maße: 16,5 x 6,8 x 1,8 cm W Werbedruck. Fläche: 80 x 40 mm Preis/Stk.: ab 25 Stück 1,50 D Digitaldruck 4c. Fläche: 140 x 50 Preis/Stk.:mmab 25 Stück 3,50 Datenhandling: einmalig 29,201 677 weiß ab 3,49 201 669 schwarz ab 3,49 STÜCKAB STÜCK-PREIS 1.DRUCKFARBE DIGITAL4C 1 6,49–25 5,99 1,503,50 505,49 1,10 2,75 100 4,99 -,80 2,250 4,49 -,60 1,50 500 3,99 -,501,25 1.000 3,49 -,30 -,75 Druckkosten weitere Farben: siehe Onlineshop 3 COB ALUMINIUM TASCHENLAMPE MIT MAGNET Diese leistungsstarke Taschenlampe hält Ihnen die Hände frei. Dank integriertem Magnet lässt sie sich genau dort platzieren, wo Sie das Licht gerade benötigen. Dank ultraheller COB-Lichtleiste beleuchtet sie auch große Flächen effektiv. Batterie AAA enthalten. Maße: Ø 1,5 x 12 cm L Lasergravur. Fläche: 30 x 12 Preis/Stk.:mmab 40 Stück -,95 Werkzeugkosten: Siehe Serviceseiten 195 618 schwarz ab 2,49 195 626 silber ab 2,49 STÜCKAB STÜCK-PREIS GRAVURLASER1 4,25 40 3,95 -,95 100 3,75 -,75 250 3,35 -,65 500 2,95 -,55 1.000 2,65 -,45 2.500 2,49 -,35 3 COB TASCHENLAMPEALUMINIUM MIT MAGNET ab 2 49




































idealzumSport 3 REFLEX-CLACKARMBAND ab 0 58 3 REFLEX-CLACK-ARMBAND Reflektierendes Armband aus Kunststoff. Für alle Armgrößen (bei Kindern auch für die Beine) geeignet. Leicht anschlagen und es wickelt sich rund um den Arm. Große Werbefläche. Maße: ca. 32 x 3,2 cm W Werbedruck. Fläche: max. ca. 140 x 20mm Preis/Stk.: ab 150 Stück -,36 Werkzeugkosten: Siehe Serviceseiten 129 224 gelb ab -,58 133 366 orange ab -,58 STÜCKAB STÜCK-PREIS 1.DRUCKFARBE 1 -,75 150 -,68 -,36 300 -,65 -,33 1.000 -,62 -,30 2.500-,58 -,25 Druckkosten weitere Farben: siehe Onlineshop Lieferung nur für den gewerblichen Bedarf. Alle Preise zzgl. MwSt.158 | WERBEIDEEN 2 WorklightReChargeTechMETMAXXARBEITSLEUCHTE Das ideale Worklight: umweltfreundlich wiederaufladbar, ultrakompakt, faltbar, magnetisch und clipbar. Mit kombinierter Fernlicht und COB-Arbeitsausleuchtung. Griffsympatischer Kunsstoff mit Aluminium, 600 mAh, LED 3 Watt, Dual COB weiß/rot 120 lumen, Blinklicht. Maße: 19,4 x 2,5 x 1 cm W Werbedruck. Fläche: 60 x 10 mm Preis/Stk.: ab 12 Stück 2,50 Werkzeugkosten: Siehe Serviceseiten. 214 318 ab 6,95 STÜCKAB STÜCKPREIS 1.DRUCKFARBE 1 9,95 12 9,45 2,50 25 9,35 1,50 50 9,25 1,100 8,65 -,90 300 7,75 -,80 600 6,95 -,70 Druckkosten weitere Farben: siehe Onlineshop 2 METMAXX ARBEITSLEUCHTEWorklightReChargeTech ab 6 95 1 LED-LAMPE „SONDA“ mit Zugfunktion Ganz im Stile einer klassischen Glühbirne samt Gehäuse erscheint diese originelle 1-Watt-LED-Lampe aus Kunststoff und schenkt Ihnen – ganz ohne Elektroanschluss – überall dort Licht, wo Sie es gerade benötigen. Mit Zugfunktion zum An- und Ausschalten, inklusive 3 AAA-Batterien. Maße: 15,7 x 5,5 cm. Kordellänge 120 cm W Werbedruck. Fläche: 20 x 40 mm Preis/Stk.: ab 30 Stück -,85 Werkzeugkosten: Siehe Serviceseiten. 162 466 schwarz ab 2,25 162 474 rot ab 2,25 162 482 blau ab 2,25 162 499 grün ab 2,25 STÜCKAB STÜCK-PREIS 1.DRUCKFARBE 3013,953,25 -,85 100 2,95 -,70 250 2,85 -,60 500 2,75 -,40 1.500 2,45 -,30 2.500 2,25 -,25 Druckkosten weitere Farben: siehe Onlineshop 1 LED-LAMPE „SONDA“ ab 2 25














































3 COB ARBEITSLAMPE ab 4 95 Bitte gleich mitbestellen: PANASONIC ALKALI-BATTERIEN „EXTREME POWER“, MIGNON „AA“ Set / 4 Stk. 285 079 2,59
„EASYmaxx“ Power-Funktionstaschenlampe leuchtet bis zu 40 x
4fach Magnet und Schalter auf der Rückseite 1 EASYMAXX SECURITY POWER TASCHENLAMPE 12 95 1 POWER TASCHENLAMPE
einen
als herkömmliche Taschenlampen und
2 LED„REEVE-AUGUSTA“TASCHENLAMPE
Ihre Sicherheit entwickelte Einstellung hält durch extrem blendendes und blinkendes Licht unerwünschte Personen fern. Material: Leichtmetall. Maße: ca. 13,6 x 3,5 x 2,8 cm Hinweis: Leistung: 4,5 V, 3x AAA Batterien – im Lieferumfang enthalten. 89 176 772 12,95 10 W 159WERBEIDEEN | STÜCKAB STÜCK-PREIS 1.DRUCKFARBE 2017,957,75 1,50 507,25 1,20 150 6,95 -,95 5005,95 -,75 1.000 4,95 -,50 Druckkosten weitere Farben: siehe Onlineshop 3 COB ARBEITSLAMPE Leistungsstarkes, batteriebetriebenes 10 W COB-Licht, mit dem Sie auch an schwer zugänglichen Stellen Licht ins Dunkel bringen. Besonders praktisch: Die Lampe kann nicht nur per Aufsteller, sondern auch mit integriertem Magnet besonders flexibel befestigt werden. Maße: 13,7 x 4 x 10,2cm Hinweis: Betrieb über 4 x AA MignonBatterien, nicht im Lieferumfang enthalten. W Werbedruck Fläche: 40 x 10 mm Preis/Stk.: ab 20 Stück 1,50 Werkzeugkosten:
Echte Erleuchtung bietet diese LEDMetalltaschenlampe, die über eine Hauptleuchte mit Dauer- und Blinklicht und verstellbarem Lichtkegel sowie eine leistungsstarke, seitliche COB-Stableuchte verfügt. Die Taschenlampe wird über das beigefügte USB-Ladekabel aufgeladen, hat ein Griffband und liegt in einer stabilen Aufbewahrungsbox. Mit integriertem Akku. Maße: 9 x Ø 2,6 cm (Lampe) W Werbedruck. Fläche: 30 x 10 mm Preis/Stk.: ab 25 Stück 1,40 Werkzeugkosten: Siehe Serviceseiten. 204 841
Die heller erzeugt strahlend hellen Lichtkegel. Die Lichtkegel-Intensität ist schnell und stufenlos einstellbar und daher für jeden Bedarf geeignet. Das Licht der handlichen, kompakten und sehr robusten Taschenlampe ist sogar aus weiter Entfernung klar sichtbar. Darüber hinaus verfügt die „EASYmaxx“ Power-Funktionstaschenlampe über 5 Leuchtmodi. Hier können Sie zwischen leichter, mittlerer oder starker Lichtintensität wählen und im Notfall sogar ein SOS-Signal senden. Eine weitere Besonderheit der „EASYmaxx“ Power-Funktionstaschenlampe ist die Schocklicht-Funktion: Diese speziell für Siehe Serviceseiten. 200 571 ab 4,95
ab 4,95 STÜCKAB STÜCK-PREIS 1.DRUCKFARBE 1 7,95 25 6,95 1,40 1006,45 -,95 200 5,95 -,85 5005,45 -,70 1.000 4,95 -,50 Druckkosten weitere Farben: siehe Onlineshop 2 LED-TASCHENLAMPE „REEVE-AUGUSTA“ ab 4 95





































es nicht im Einsatz ist, kann es per Clip ganz einfach am Gürtel oder Hemd befestigt werden. Maße: 9,5 x 3,5 x 1 cm W Werbedruck. Fläche: 35 x 10 mm Preis/Stk.: ab 25 Stück 1,30 L Laserbeschriftung. Fläche: 35 x 10 Preis/Stk.:mmab 25 Stück 1,50 Werkzeugkosten: Siehe Serviceseiten. 133 850 blau ab 3,95 133 868 grün ab 3,95 133 876 rot ab 3,95 STÜCKAB STÜCK-PREIS 1.DRUCKFARBE GRAVURLASER Druckkosten1.0003,95-,70-,805004,25-,80-,902504,55-,901,-1004,851,-1,20255,151,301,5015,45weitereFarben:sieheOnlineshop
250 205SCHNEIDERUNIVERSAL-519groß 205.-WERBETIPP* Schlaghammer Gurtschneider Gurtclip2 „BIGMULTIFUNKTIONSWERKZEUGR“ Mit diesem Multifunktions-Werkzeug haben Sie immer alles sofort im Griff haben. Im Geschenkkarton. Funktionen: 2 Klingen, Schere, Kapselheber, Korkenzieher, Schraubenzieher, Säge und Schlüsselring. Maße: ca. 11 x 3 x 2 cm Ä Ätzung. Fläche: auf großer Klinge: 35 x 6 Preis/Stk.:mm ab 35 Stück 1,05 W Werbedruck. Fläche: auf Schale, 30 x 4 mm Preis/Stk.: ab 35 Stück -,90 Werkzeugkosten: Siehe Serviceseiten. 115 540 ab 2,25 STÜCKAB STÜCK-PREIS 1.DRUCKFARBE ÄTZUNG 100353,59-,901,0513,79 3,29 Druckkosten5002,25-,50-,702502,60-,60-,75-,70-,85weitereFarben:sieheOnlineshop 2 MULTIFUNKTIONSWERKZEUG „BIG R“ ab 2 25 Lieferung nur für den gewerblichen Bedarf. Alle Preise zzgl. MwSt.160 | WERBEIDEEN 4 UNIVERSAL-SCHNEIDER KLEIN ab 0 29 3 UNIVERSALGROSSSCHNEIDER ab 0 45 1 SICHERHEITSMESSER ab 3 95 3 UNIVERSAL-SCHNEIDER groß Kunststoffgehäuse, 7 breite Klingenabschnitte, austauschbar. Maße: 15 cm lang W Werbedruck. Fläche: 90 x 9 mm Preis/Stk.: ab 250 Stück -,16 Werkzeugkosten: Siehe Serviceseiten. 041 206 ab -,45 STÜCKAB STÜCK-PREIS 1.DRUCKFARBE 1 -,61 250 -,57 -,16 500 -,55 -,15 1.000 -,53 -,14 2.000 -,51 -,13 4.000 -,45 -,12 Druckkosten weitere Farben: siehe Onlineshop
4 UNIVERSAL-SCHNEIDER klein Kunststoffgehäuse mit Klipp. 12 Klingenabschnitte, austauschbar Maße: 12 cm lang W Werbedruck. Fläche: 60 x 6 mm Preis/Stk.: ab 300 Stück -,14 Werkzeugkosten: Siehe Serviceseiten. 041 183 ab -,29 STÜCKAB STÜCK-PREIS 1.DRUCKFARBE 1 -,42 300 -,39 -,14 1.000 -,36 -,13 2.500 -,32 -,12 5.000 -,29 -,11 Druckkosten weitere Farben: siehe Onlineshop
1 SICHERHEITSMESSER Ein Taschenmesser, das bei Handwerkern und Rettungskräften sehr beliebt ist. Dank integriertem Hammer, Gurtschneider und großer Klinge ist das schwere Messer mit Metallgehäuse ein perfekter Allrounder. Wenn























































1,80
29,216 456 weiß ab 1,95 220 453 gelb ab 1,95 STÜCKAB STÜCK-PREIS 1.DRUCKFARBE DIGITAL4C 4013,553,25 -,951,80 150 3,05 -,65 1,35 300 2,85 -,551,10 600 2,55 -,50-,90 1.000 2,25 -,45-,80 3.000 1,95 -,35-,70 Druckkosten weitere Farben: siehe Onlineshop DRUCK4C 1 HOLZ-ZOLLSTOCKADGA250,2M ab 1 95 161WERBEIDEEN |* Komplettpreis inklusiv einfarbigem, einseitigen Werbeaufdruck in Standardschrift
MADESPITZENQUALITÄTINGERMANY beiArretiertexakt90°MitWinkelanzeige 1 HOLZ-ZOLLSTOCK ADGA 250 2 Meter
Der Qualitäts-Zollstock verfügt über Präzisionsfedern aus gehärtetem Stahl. Dies sichert eine verschleißfreie und dauerhafte Federung. Das Gelenk mit innenliegenden gehärteten Stahlfedern bleibt immer leichtgängig und exakt bei 90° oder 180° arretierbar. Ohne Freileiste, mit Produkthaftungskennzeichnung und Winkelanzeige in der Innenseite des 1. Gliedes. Made in Germany W Werbedruck. Fläche: seitlich 130 x 25 mm Preis/Stk.: ab 40 Stück -,95 Werkzeugkosten: Siehe Serviceseiten. D Digitaldruck. Fläche: seitlich 230 x 26 mm Preis/Stk.: ab 40 Stück Datenhandling: einmalig











































MASSARBEIT 90 116RINGSCHLÜSSEL-STÖCKEMINI-ZOLL-MIT884 199.-WERBETIPP* 100 0331STÖCKEMINI-ZOLL-KUNSTSTOFFMETER907 249.-WERBETIPP* 1852STÖCKEZOLL-KUNSTSTOFF-METER059 199.-WERBETIPP DRUCKDRUCKDRUCK4C4C4C Lieferung nur für den gewerblichen Bedarf. Alle Preise zzgl. MwSt.162 | WERBEIDEEN 3 ZOLLSTOCK mit Schlüsselring 50 cm Ein idealer Schlüsselanhänger für unterwegs. Der 50 cm lange Zollstock ist aus Kunststoff. Maße: 6,5 x 2,3 x 1,2 cm W Werbedruck. Fläche: 40 x 15 mm Preis/Stk.: ab 100 Stück -,42 D Digitaldruck 4c. Fläche: 45 x 18 mm Preis/Stk.: ab 100 Stück -,90 Datenhandling: einmalig 29,199 620 ab 1,09 1 KUNSTSTOFF-ZOLLSTOCK 2 Meter Bruchfester Kunststoff. 10 Glieder, schwarze Zentimetereinteilung. Federnde Kunststoffgelenke, genietet. Maße: 23 x 2,7 x 1,4 cm W Werbedruck. Fläche: 130 x 20 mm Preis/Stk.: ab 50 Stück -,64 D Digitaldruck 4c. Fläche: 227 x 25 mm Preis/Stk.: ab 50 Stück 1,55 Datenhandling: einmalig 29,041 845 ab 1,79 1 ZOLLSTOCKKUNSTSTOFF-2 M ab 1 79 2 ZOLLSTOCKKUNSTSTOFF-1 M ab 1 29 3 ZOLLSTOCK SCHLÜSSELRINGMIT ab 1 09 STÜCKAB STÜCKPREIS 1.DRUCKFARBE DIGITAL4C 1 2,69–50 2,39-,64 1,55 150 2,29 2.5001,795002,19-,521,25-,591,35 -,42 -,95 Druckkosten weitere Farben: siehe Onlineshop 2 KUNSTSTOFF-ZOLLSTOCK 1 Meter Aus elastischem Fiberglas mit Platz für Ihren Firmenschriftzug. 10 Glieder, schwarze Zentimetereinteilung. Federnde Kunststoffgelenke, genietet. Maße: 13 x 2,6 x 1,3 cm W Werbedruck. Fläche: 90 x 18 mm Preis/Stk.: ab 80 Stück -,40 D Digitaldruck 4c. Fläche: 120 x 20 mm Preis/Stk.: ab 80 Stück -,95 Datenhandling: einmalig 29,110 377 ab 1,29 STÜCKAB STÜCKPREIS 1.DRUCKFARBE DIGITAL4C 7001,653001,75-,37-,85801,85-,40-,9511,89 -,34 3.0001,291.5001,49-,28-,55-,70 -,24 -,45 Druckkosten weitere Farben: siehe Onlineshop STÜCKAB STÜCK-PREIS 1.DRUCKFARBE DIGITAL4C 1001,5911,65 -,42 -,90 5001,49 -,32 5.0001,092.5001,19-,27-,601.0001,39-,30-,65-,75 -,26 -,55 Druckkosten weitere Farben: siehe Onlineshop 4 BUCHENHOLZ-ZOLLSTOCK 2 Meter Aus bruchfestem Buchenholz mit Platz für Ihre Firmenwerbung. 10 Glieder mit innenliegenden Stahlfedern, weiß lackiert, Zentimetereinteilung schwarz. W Werbedruck. Fläche: Breitseite 130 x 25 mm Preis/Stk.: ab 60 Stück -,65 Werkzeugkosten: Siehe Serviceseiten. 207 489 ab 2,19 STÜCKAB STÜCK-PREIS 1.DRUCKFARBE 1 2,99 602,79 -,65 150 2,69 -,55 5002,59 -,50 1.000 2,49 -,40 2.500 2,39 -,30 5.0002,19 -,25 Druckkosten weitere Farben: siehe Onlineshop 4 ZOLLSTOCKBUCHENHOLZ-2M ab 2 19



































GENAUERWERBENWERBEN mit Gürtelklipp Mit Winkeleinteilung 45 151151ZOLLSTÖCKEBUCHENHOLZ-STABILA664weiß672gelb 195.-WERBETIPP* DRUCK4C 100 108BANDMASSEMULTI-591 199.-WERBETIPP* 163WERBEIDEEN | 2 STABILA ZOLLSTOCKQUALITÄTS-700ERSERIE 2 Meter Hochwertiges Buchenholz, speziell ausgesucht für optimale Bruchfestigkeit und Elastizität. Integriertes Winkelschema zum schnellen Anlegen und Übertragen häufig verwendeter Winkel. Wartungsfreie, glasfaserverstärkte Polyamid-Gelenke. 220 461 schwarz ab 2,75 4 MULTI-BANDMASS 2 Meter Praktisches 2 m Maßband mit 3 weiteren Funktionen: Wasserwaage, Mini-Kugelschreiber und integriertem Haftnotizblock. Metallmaßband mit Rückholfeder. Gelber Feststellklipp. Gürtelklipp auf der Rückseite integriert. Gehäuse aus robustem Kunststoff. Maße: ca. 8 x 6 x 3 cm W Werbedruck. Fläche: auf der Abdeckung des Notizblocks: ca. 35 x 30 mm Preis/Stk.: ab 100 Stück -,37 Werkzeugkosten: Siehe Serviceseiten. 129 634 ab -,99
ab
ab 2,49 STÜCKAB 400ERSERIE 700ERSERIE 1.DRUCKFARBE DIGITAL4C Druckkosten2.5001,992,75-,45-,851.5002,252,95-,50,-952002,803,65-,651,30503,103,95-,701,4513,254,15––5002,653,25-,551,10weitereFarben:sieheOnlineshop STÜCKAB STÜCKPREIS 1.DRUCKFARBE 1 1001,401,55 -,37 5001,30 -,29 1.0001,15 -,27 2.5001,05 ,-24 10.000-,99 -,19 Druckkosten weitere Farben: siehe Onlineshop 3M STÜCKAB STÜCK-PREIS 1.DRUCKFARBE 502,5512,69 -,60 1502,35 -,55 5002,05 -,50 2.5001,89 -,37 Druckkosten weitere Farben: siehe Onlineshop 5M STÜCKAB STÜCK-PREIS 1.DRUCKFARBE 403,0913,19 -,60 1502,99 -,55 5002,79 -,50 1.5002,49 -,45 Druckkosten weitere Farben: siehe Onlineshop 3 „BLACKMASSBANDMAGIC “ ab 1 89 1 STABILA 400ZOLLSTOCKQUALITÄTS-2MERSERIE ab 1 99 4 2MULTI-BANDMASSMETERLANG ab 0 99 1 STABILA ZOLLSTOCKQUALITÄTS-400ERSERIE 2 Meter Der Buchenholz-Zollstock der den Maßstab setzt. Mit neuem patentierten Federgelenk. Das verwendete Buchenholz stammt aus nachhaltig bewirtschafteten Wäldern. Ein Qualitätsprodukt hergestellt in Europa. 155 196 weiß ab 1,99 137 891 gelb ab 1,99 Druckangaben für Pos. 1 und 2: W Werbedruck. Fläche: 130 x 25 mm Preis/Stk.: ab 50 Stück -,70 Werkzeugkosten: Siehe Serviceseiten. D Digitaldruck 4c. Fläche: 230 x 26 Preis/Stk.:mmab 50 Stück 1,45 Datenhandling: einmalig 29,2 STABILA 700ZOLLSTOCKQUALITÄTS-2MERSERIE ab 2 75 * Komplettpreis inklusiv einfarbigem, einseitigen Werbeaufdruck in Standardschrift
3 MASSBAND „BLACK MAGIC“ Die leicht gummierte Oberfläche sorgt dafür, dass dieses Maßband besonders gut in der Hand liegt. Auf der weiß abgesetzten Außenseite kommt Ihr Werbeaufdruck perfekt zur Geltung. Mit Gürtelklipp und Trageschlaufe. W Werbedruck. Fläche: auf 3 m Massband, 30 x 15 mm Preis/Stk.: ab 50 Stück -,60 W Werbedruck. Fläche: auf 5 m Massband: 40 x 15 mm Preis/Stk.: ab 40 Stück -,60 Werkzeugkosten: Siehe Serviceseiten. 160 840 3 Meter 1,89 160 858 5 Meter









































































































Frische-Verschluss DRUCK4C Lieferung nur für den gewerblichen Bedarf. Alle Preise zzgl. MwSt.164 | WERBEIDEEN 2 LUNCH-BOX GEFROSTET Praktische Kunststoffbox, ideal für den Arbeitsplatz oder Schule/Kindergarten. Bietet innen viel Platz und außen eine große Werbefläche, auf Anfrage Oberseite ganzflächig bedruckbar. Kunststoff für Lebensmittel geprüft. Maße: ca. 18 x 12,5 x 6,5 cm W Werbedruck. Fläche: 110 x 60 Preis/Stk.:mmab 100 Stück -,40 Werkzeugkosten: Siehe Serviceseiten. D Digitaldruck 4c. Fläche: 120 x 75 Preis/Stk.:mmab 100 Stück -,95 Datenhandling: einmalig 29,284 897 blau ab -,89 284 901 rot ab -,89 133 044 weiß ab -,89 133 052 grün ab -,89 2 LUNCHBOX ab 0 89 STÜCKAB STÜCK-PREIS 1.DRUCKFARBE DIGITAL4C Druckkosten5.000-2.500-1.00050010011,39–1,29-,40-,951,15-,36-,851,05-,33-,75,99-,29-,65,89-,25-,45weitereFarben:sieheOnlineshop 1 BROTDOSE Ob in der Schule oder im Büro – mit einer Brotdose ziehen Sie in den Alltag Ihrer Kunden ein und werden mit Ihrer Werbebotschaft zum täglichen Begleiter. BPA-frei. Maße: 15 x 11 x 5,5 cm W Werbedruck. Fläche: 80 x 40 Preis/Stk.:mmab 120 Stück -,34 Werkzeugkosten: Siehe Serviceseiten. D Digitaldruck 4c. Fläche: 100 x 60 Preis/Stk.:mmab 120 Stück -,70 Datenhandling: einmalig 29,180 846 blau ab -,89 180 854 rot ab -,89 180 862 weiß ab -,89 180 879 grün ab -,89 STÜCKAB STÜCK-PREIS 1.DRUCKFARBE DIGITAL4C Druckkosten3.0001.00050025012011,49–1,29-,34-,701,19-,32-,651,09-,29-,60-,99-,24-,55-,89-,22-,45weitereFarben:sieheOnlineshop 1 BROTDOSE ab 0 89 DRUCK4C

















































































3 SONNENBRILLE „BICOLOUR“
Druckkosten2.0001.0001004012,95–2,75-,801,602,65-,751,502502,55-,651,405002,35-,551,102,05-,45-,901,95-,40-,80weitereFarben:sieheOnlineshop
2 UNTERSETZER TRIKOT MIT ÖFFNER 1 Artikel = 2 Funktionen. Untersetzer in Trikot-Form aus ABS mit integriertem Flaschenöffner. Die Bodenfläche ist mit einem EVA-Badge versehen, welches einen Anti-Rutsch-Effekt garantiert. Maße: 10 x 9,8 x 0,4 cm W Werbedruck. Fläche: Oberseite 50 x 50 mm Preis/Stk.: ab 100 Stück -,35 Werkzeugkosten: Siehe Serviceseiten. D Digitaldruck. Fläche: Oberseite 50 x 50 mm Preis/Stk.: ab 100 Stück -,75 Datenhandling: einmalig 29,220 566 weiß ab -,75 2 UNTERSETZER TRIKOT MIT ÖFFNER ab 0 75 Rückseite
Siehe Serviceseiten. D Digitaldruck. Fläche: Oberseite 80 x 80 mm Preis/Stk.: ab 40 Stück 1,60 Datenhandling: einmalig 29,223 621 grün ab 1,95 223 630 blau ab 1,95 223 648 orange ab 1,95 223 656 rot ab 1,95 223 664 weiß ab 1,95 1 BROTDOSE „SANDWICH“ ab 1 95 DRUCK4C
1 BROTDOSE „SANDWICH“ Praktische Brotdose in Form eines Sandwiches. Die Brotdose ist aus einem Teil gefertigt. Mit einem Clip auf der Vorderseite zum Verschließen der Box. Hergestellt in Deutschland. Mikrowellenbeständig, nicht spüllmaschinengeeignet. Maße: 14 x 13,5 x 6,5 cm W Werbedruck. Fläche: Oberseite 60 x 60 mm Preis/Stk.: ab 40 Stück -,80 Werkzeugkosten:
WERBEIDEENVIELFÄLTIGKE STÜCKAB STÜCK-PREIS 1.DRUCKFARBE DIGITAL4C Druckkosten5.0003.0001.00050010011,45–1,30-,35-,752501,20-,30-,651,10-,25-,50-,95-,20-,40-,85-,17-,30-,75-,14-,20weitereFarben:sieheOnlineshop
Sonnenbrillen zählen zu den beliebtesten Sommer-Accessoires. Diese bunt verspiegelten Modelle mit zweifarbigem Kunststoffgestell bieten nicht nur perfekten UV 400 Schutz, sondern zugleich beste Möglichkeiten, Ihr Logo in die Welt zu tragen. Maße: 14,5 x 15,5 x 4,7 cm W Werbedruck. Fläche: auf Bügel 40 x 7 mm Preis/Stk.: ab 80 Stück -,45 Werkzeugkosten: Siehe Serviceseiten. 183 527 blau ab -,99 183 535 rot ab -,99 183 543 weiß ab -,99 STÜCKAB STÜCK-PREIS 1.DRUCKFARBE 1 1,89 80 1,69 -,45 150 1,59 -,40 300 1,49 -,35 1.500 1,19 -,30 5.000 -,99 -,25 Druckkosten weitere Farben: siehe Onlineshop 3 „BICOLOUR“SONNENBRILLE ab 0 99 165WERBEIDEEN |
DRUCK4C STÜCKAB STÜCK-PREIS 1.DRUCKFARBE DIGITAL4C













































































































































Verschieden große und farbige Haftnotizzettel enthält dieses kleine praktische Buch aus stabilem, weißem Karton.
DRUCK4C Lieferung nur für den gewerblichen Bedarf. Alle Preise zzgl. MwSt.166 | WERBEIDEEN IHRE BOTSCHAFT IN SIGNALFARBEN 2 TEXTMARKER „BLUME“ Blumen sagen mehr als tausend Worte – das gilt auch in der Kundenbindung. Vor allem, wenn sie so dekorativ auf dem Schreibtisch Ihrer Kunden stehen. Die Blätter dieser bunten Blüte sind Textmarker in fünf leuchtenden Farben. Maße: 11 x 2 x 6 cm W Werbedruck. Fläche: 35 x 12 mm Preis/Stk.: ab 90 Stück -,38 Werkzeugkosten: siehe Serviceseiten. D Digitaldruck 4c. Fläche: 40 x 20 Preis/Stk.:mmab 90 Stück -,95 Datenhandling: einmalig 29,152 946 ab -,99 STÜCKAB STÜCKPREIS 1.DRUCKFARBE DIGITAL4C Druckkosten5.000-,99-,25-,451.5001,19-,30-,657001,29-,32-,752501,39-,35-,85901,4511,55––-,38-,95weitereFarben:sieheOnlineshop 2 TEXTMARKER „BLUME“ ab0 99 1 TEXTMARKER „STERN“ Wir holen für Sie die Sterne vom Himmel. Und zwar ganz besonders leuchtende. Denn in den Zacken dieses Sterns verbergen sich leuchtende Textmarker. Maße: 11,5 x 11,5 x 1,8 cm W Werbedruck. Fläche: 40 x 30 mm Preis/Stk.: ab 100 Stück -,35 Werkzeugkosten: Siehe Serviceseiten. D Digitaldruck 4c. Fläche: 50 x 50 Preis/Stk.:mmab 100 Stück -,80 Datenhandling: einmalig 29,179 385 ab 1,29 STÜCKAB STÜCK-PREIS 1.DRUCKFARBE DIGITAL4C Druckkosten10.0005.0002.0001.00030010011,99–1,89-,35-,801,79-,32-,751,69-,28-,651,59-,25-,601,49-,22-,551,29-,19-,50weitereFarben:sieheOnlineshop 1 TEXTMARKER „STERN“ ab 1 29 4 TEXTMARKER „LIKE“ Daumen hoch für diesen Textmarker! Jeder einzelne Finger ist ein leuchtender Markerstift und die Handfläche bietet beste Möglichkeiten für Ihre Werbeanbringung. Maße: 9 x 7,5 x 1,5 cm W Werbedruck. Fläche: 45 x 30 mm Preis/Stk.: ab 60 Stück -,60 Werkzeugkosten: Siehe Serviceseiten. D Digitaldruck 4c. Fläche: 50 x 40 Preis/Stk.:mmab 60 Stück 1,15 Datenhandling: einmalig 29,175 438 ab 1,95 STÜCKAB STÜCK-PREIS 1.DRUCKFARBE DIGITAL4C Druckkosten2.5005002506012,75–2,65-,601,152,45-,501,-2,25-,45-,901,95-,40-,80weitereFarben:sieheOnlineshop 4 „LIKE“TEXTMARKER ab 1 95 3 HAFTNOTIZEN-SET
1 gelber Block 10 x 7,5 cm (100 Blatt), 1 gelber Block 7,5 x 5 cm (25 Blatt) und je 5 bunte Blöcke (4,5 x 1,2 cm) à 25 Blatt sorgen dafür, dass immer die richtige Größe greifbar ist. Große Werbefläche. Maße: zugeklappt ca. 10,5 x 8 x 1,5 cm W Werbedruck. Fläche: 60 x 40 mm Preis/Stk.: ab 100 Stück -,45 Werkzeugkosten: Siehe Serviceseiten. D Digitaldruck 4c. Fläche: 70 x 90 Preis/Stk.:mmab 100 Stück -,90 Datenhandling: einmalig 29,081 301 ab -,69 3 HAFTNOTIZEN-SET ab0 69 STÜCKAB STÜCKPREIS 1.DRUCKFARBE DIGITAL4C Druckkosten5.000-,692.500-,891.000-,994001,091001,1911,29––-,45-,90-,42-,85-,35-,75-,30-,65-,25-,50weitereFarben:sieheOnlineshop DRUCK4CDRUCK4C DRUCK4C










































































3 SCHREIBMAPPE „OFFICE-SET“ Smarte Schreibmappe für alle, die auch unterwegs keine Kompromisse eingehen möchten. Neben zwei Linealen, Bleistiften, Kugelschreiber, Anspitzer und Radiergummi enthält die Mappe aus festem Karton auch Haftnotizen und transparente Haftpfeile sowie einen Notizblock. Maße: 15 x 21 x 2 cm W Werbedruck. Fläche: 80 x 30 Preis/Stk.:mmab 20 Stück 1,10 Werkzeugkosten: Siehe Serviceseiten. 179 377 ab 2,95 3 „OFFICE-SET“SCHREIBMAPPE ab 2 95 STÜCKAB STÜCK-PREIS 1.DRUCKFARBE 2015,355,15 1,10 50 4,95 1,100 4,45 -,85 250 3,95 -,65 500 3,45 -,50 1.000 2,95 -,40 Druckkosten weitere Farben: siehe Onlineshop 167WERBEIDEEN | 2 NOTIZBUCH „POCKET“ Der Klassiker mit dem praktischen Gummiverschluss und Leseband. Dieses Notizbuch im A6-Format mit 100 Seiten ist ein gerne gesehener Begleiter – und der ideale Träger von Ihrem Firmenlogo und Werbebotschaften. In den Farben Weiß, Blau, Gelb, Pink, Grün sowie Rot und Schwarz erhältlich. Maße: 9 x 14 x 1,3 cm W Werbedruck. Fläche: 45 x 25 mm Preis/Stk.: ab 100 Stück -,45 Werkzeugkosten siehe Serviceseiten. 121 492 weiß ab -,79 121 505 blau ab -,79 121 513 gelb ab -,79 121 521 pink ab -,79 121 530 grün ab -,79 175 270 schwarz ab -,79 173 241 rot ab -,79 2 „POCKET“NOTIZBUCH ab0 79 STÜCKAB STÜCK-PREIS 1.DRUCKFARBE 1 1,25 100 1,15 -,45 300 1,09 -,40 600 -,99 -,35 1.500-,89 -,30 2.500-,79 -,25 Druckkosten weitere Farben: siehe Onlineshop 1 NOTIZBUCH „AUTHOR“ So macht Schreiben Spaß! Klassisches DIN-A5-Notizbuch mit erfrischend weißem Einband. Innen warten 80 cremeweiße, linierte Seiten auf kluge Worte, Notizen und Ideen. Mit farbigem Gummiband zum Verschließen. Maße: 20,7 x 14,2 x 1,2 cm W Werbedruck. Fläche: 80 x 50 mm Preis/Stk.: ab 70 Stück -,55 Werkzeugkosten: Siehe Serviceseiten. D Digitaldruck 4c. Fläche: 80 x 60 Preis/Stk.:mmab 70 Stück 1,05 Datenhandling: einmalig 29,171 459 schwarz ab 1,39 171 467 blau ab 1,39 171 475 grün ab 1,39 171 483 orange ab 1,39 181 429 rot ab 1,39 1 „AUTHOR“NOTIZBUCH ab1 39 STÜCKAB STÜCKPREIS 1.DRUCKFARBE DIGITAL4C Druckkosten2.5001,39-,30-,651.0001,60-,35-,755001,85-,40-,851502,15-,50-,95702,25-,551,0512,35––weitereFarben:sieheOnlineshop DRUCKDRUCK4C4C


































































































































































AUCH AUS RECYCLING -PAPIER ERHÄLTLICH DIN A5 DIN A4 50 x 75 mm 100 x 75 mm 100 x 100 mm (nur weiß) 2 A4NOTIZBLOCK ab 1 75 DRUCK4CNEU Lieferung nur für den gewerblichen Bedarf. Alle Preise zzgl. MwSt.168 | WERBEIDEEN
1 INKL. 4C DRUCK Haftnotizblöcke, je 50 Blatt, gummiert, Farben weiß oder pastellgelb, Papierqualität 80g/m2 W Werbedruck erfolgt auf jedem Blatt. Lieferzeit ca. 20 Arbeitstage nach Druckfreigabe. Mehr-/Minderlieferungen bis 10% sind produktionstechnisch bedingt möglich. Preise, Formate und Werbedruck siehe Tabelle. Keine weiteren Vorkosten! Weitere Papierfarben ab 1.000 Stück auf Anfrage.
HAFTNOTIZBLÖCKE
2 NOTIZBLOCK DIN A4/A5 Notizblock (A4/A5) mit 50 Blatt aus weißem Offsetoder Recycling-Papier, je 80 g/m2 Verarbeitung: Am Kopf an Pappunterlage geleimt. Unterkarton aus Graupappe. Recyclingpapier – hergestellt aus 100 % Altpapier mit dem Umweltzeichen „Blauer Engel“ Qualität „Made in Germany“ Maße: A5 ca. 14,8 x 21 cm, A4 21 x 29,7 cm D Digitaldruck. Fläche: auf A5 140 x 40 mm, auf A4 200 x 40 mm,
ab 100 Stück möglich. Datenhandling: einmalig 29,-. Lieferzeit ca. 3 Wochen. Inklusive 4c-Digitaldruck (wahlweise blanko, liniert, kariert oder eigene Motive) 201 923 DIN A4 ab 1,75 201 940 DIN A4 Recycling ab 1,95 201 931 DIN A5 ab -,95 201 958 DIN A5 Recycling ab 1,15 2 A5NOTIZBLOCK ab 0 95 1 INKL.HAFTNOTIZBLOCK,4CDRUCK ab 0 35 Artikel Nr. 106 508 106 428 Format mm 100 x 75 50 x 75 AB STÜCK INKL. 4CINKL. 4C 250 1,95 1,75 500 1,40 1,25 1.000 -,95 -,75 2.000 -,65 -,55 5.000 -,50 -,45 STÜCKAB WEISSA4 RECYCLINGA4 WEISSA5 RECYCLINGA5 100 3,45 4,45 2.0001,751,95-,951,151.0001,952,351,251,455002,252,951,451,652002,653,451,851,952,202,65 Artikel Nr. 083 776 106 469 083 792 Format mm 100 x 75 100 x 100 50 x 75 AB STÜCK INKL. 4CINKL. 4CINKL. 4C 250 1,79 2,25 1,65 500 1,291,75 1,15 1.000 -,89 1,25 -,65 2.000 -,59 -,95 -,45 5.000 -,49 -,85 -,35 HAFTNOTIZBLÖCKE WEISS HAFTNOTIZBLÖCKE GELB Alle Preise inkl. 4c-Digitaldruck


































Notizwürfel mit Druck 169WERBEIDEEN | 3 ZETTELBOX Kunststoff-Kubus mit „Speicherzugriff“ auf ca. 870 Blatt weißes Offsetpapier, 90 g/m2. Papier im Lieferumfang enthalten. Lieferzeit ca. 6 Wochen. Maße: 10 x 10 x 10 cm W Werbedruck. Fläche: 80 x 80 mm Preis/Stk.: ab 108 Stück pro Farbe, Motiv und Seite -,33 Einzelblattbedruckung nicht möglich. Werkzeugkosten: 58,Zettelbox, ohne Druck 113 812 gelb 3,65 113 837 blau 3,65 281 294 rot 3,65 027 919 weiß 3,65 104 338 transparent 3,65 Zettelbox, für Druck 112 145 gelb ab 2,19 112 153 blau ab 2,19 281 309 rot ab 2,19 112 137 weiß ab 2,19 112 161 transparent ab 2,19 1 NOTIZWÜRFEL ca. 900 Blatt Holzfreies Papier, weiß. Chlorfrei gebleicht. Maße: je 10 x 10 x 10 cm W Werbedruck auf alle 4 Seiten. Fläche: seitlich 95 x 95 mm Preis/Stk.: ab 108 Stück -,72 D Digitaldruck 4c auf alle 4 Seiten. Fläche: 100 x 100 mm Preis/Stk.: ab 108 Stück 2,45 Datenhandling: einmalig 58,-/Motiv Einzelblattbedruckung auf Anfrage. Lieferzeit 5 WerkzeugkostenWochen.jeFarbe: 58,Mehr- oder Minderlieferungen sind bis zu 10% möglich. 055 283 für Druck ab 2,39 119 788 ohne Druck 3,45 3 TRANSPARENTZETTELBOX ab 2 191 CA.NOTIZWÜRFEL900BLATT ab 2 39 3 ZETTELBOX ab 2 19 STÜCKAB STÜCK-PREIS 41.DRUCKFARBESEITEN DIGITAL 4C AUF ALLE 4 SEITEN 1083,45 -,72 Druckkosten2.0162,39-,491,451.0082,45-,521,555042,75-,561,752523,15-,641,952,45weitereFarben:sieheOnlineshop STÜCKAB STÜCK-PREIS 1.DRUCKFARBE 1082,7913,65 -,33 2522,59 -,30 5042,35 -,28 1.0082,25 -,26 2.0162,19 -,25 Druckkosten weitere Farben: siehe Onlineshop 108 014BOXENZETTEL-192 weiß 013 858 transparent 389.2WERBETIPP*DESIGNER-ZETTELBOX Schön gestaltete Zettelbox aus transparentem Kunststoff, die zugleich als Stiftehalter eine gute Figur auf dem Schreibtisch oder Tresen macht. 300 Blätter. Maße: 11 x 10 x 4,5 cm W Werbedruck. Fläche: 60 x 30 Preis/Stk.:mmab 60 Stück -,50 Werkzeugkosten: Siehe Serviceseiten. D Digitaldruck 4c. Fläche: 60 x 80 Preis/Stk.:mm.ab 60 Stück 1,25 Datenhandling: einmalig 29,180 887 blau ab 1,59 180 895 rot ab 1,59 180 900 schwarz ab 1,59 STÜCKAB STÜCK-PREIS 1.DRUCKFARBE DIGITAL4C Druckkosten2.5001.0005002501006012,40–2,29-,501,252,19-,451,-2,09-,40-,951,95-,35-,851,75-,30-,751,59-,25-,65weitereFarben:sieheOnlineshop 2 ZETTELBOXDESIGNERab1 59 DRUCK4C * Komplettpreis inklusiv einfarbigem, einseitigen Werbeaufdruck in Standardschrift
















































































UNDUNDMARKIERENNOTIERENNOTIEREN DRUCK4C Lieferung nur für den gewerblichen Bedarf. Alle Preise zzgl. MwSt.170 | WERBEIDEEN2 „MULTIHAFTZETTEL-BUCHMEMO“ ab 0 74 100 176„MULTIHAFTZETTEL-BÜCHERMEMO“203 159.-WERBETIPP* 2 „MULTIHAFTZETTEL-BUCHMEMO“ Ein ganzes Spiralbuch voller Haftnotizen. Ob im Format 7,5 x 5 cm oder 1,3 x 5 cm – alle Merkzettel sind jeweils in fünf Farben reichlich vorhanden. Maße: 7,5 x 7 x 2,5 cm W Werbedruck. Fläche: 40 x 20 mm Preis/Stk.: ab 100 Stück -,39 Werkzeugkosten: Siehe Serviceseiten. 122 151 ab -,74 STÜCKAB STÜCK-PREIS 1.DRUCKFARBE 100-,9811,05 -,39 500-,91 -,36 1.000-,86 -,33 2.500-,78 -,31 5.000-,74 -,25 Druckkosten weitere Farben: siehe Onlineshop 3 NOTES „MEMO-CARDHAFTNOTIZBLOCKFILMMARKER“ Diese reißfesten, bunten Haftmarker sind aus transparenter Folie und damit ideal zum vorübergehenden Markieren von Textstellen & Co. Als Block sind sie mit Ihrem Firmenlogo zugleich ein tolles Werbepräsent. Maße: 7,7 x 5,4 cm W Werbedruck. Fläche: 60 x 30 mm Preis/Stk.: ab 200 Stück -,20 Werkzeugkosten: Siehe Serviceseiten. D Digitaldruck 4c. Fläche: 60 x 30 Preis/Stk.:mmab 200 Stück -,45 Datenhandling: einmalig 29,165 590 ab -,59 3 NOTES HAFTNOTIZBLOCK FILMMARKER“„MEMO-CARDS ab 0 59 STÜCKAB STÜCK-PREIS 1.DRUCKFARBE DIGITAL4C Druckkosten10.000-,59-,13-,282.500-,69-,14-,301.000-,79-,15-,35500-,89-,17-,38200-,99-,20-,4511,10––weitereFarben:sieheOnlineshop 1 HAFTNOTIZ-HEFTCHEN So behalten Sie alles im Auge! Klassische Haftnotizen in zwei Größen und fünf Farben. Maße: 8,5 x 8 x 0,7 cm W Werbedruck. Fläche: 50 x 15 Preis/Stk.:mmab 200 Stück -,21 Werkzeugkosten: Siehe Serviceseiten. 179 310 natur ab -,39 179 328 weiß ab -,39 179 336 schwarz ab -,39 1 HEFTCHENHAFTNOTIZab 0 39 STÜCKAB STÜCK-PREIS 1.DRUCKFARBE 1 -,65 200 -,56 -,21 500 -,54 -,19 1.000 -,49 -,18 2.500 -,45 -,17 5.000 -,42 -,16 10.000 -,39 -,14 Druckkosten weitere Farben: siehe Onlineshop










































































171WERBEIDEEN | 4 BLEISTIFT MIT RADIERER „HAMMER“ Der absolute Hammer! Diese Kombination aus Zimmermannsbleistift und Radiergummi ist das perfekte Werbegeschenk für jeden Hobby- und Profihandwerker. Maße: verpackt 5 x 27,5 cm W Werbedruck. Fläche: Bleistift: 60 x 6 mm Preis/Stk.: ab 120 Stück -,35 Werkzeugkosten: Siehe Serviceseiten. 172 417 ab -,69 3 BLEISTIFT MIT RADIERER UND SPITZER „SCREWDRIVER“ Dieser Schraubenzieher hat es in sich! Denn als Kombination aus Bleistift, Radiergummi und Anspitzer ist er das ideale Werbegeschenk für alle technikaffinen Branchen. Maße: verpackt 10 x 21 cm W Werbedruck. Fläche: auf Griff: 40 x 6 mm Preis/Stk.: ab 100 Stück -,45 S Siebdruck. Fläche: Bleistift: 50 x 18 mm Preis/Stk.: ab 100 Stück -,45 Werkzeugkosten: Siehe Serviceseiten. 172 409 ab -,89 3 „SCREWDRIVER“BLEISTIFT ab 0 89 4 „HAMMER“BLEISTIFT ab 0 69 STÜCKAB STÜCK-PREIS 1.DRUCKFARBE 1001,3511,45 -,45 2501,25 -,40 5001,19 -,35 1.500-,99 -,30 3.000-,89 -,25 Druckkosten weitere Farben: siehe Onlineshop STÜCKAB STÜCK-PREIS 1.DRUCKFARBE 120-,9911,10 -,35 250-,89 -,32 500-,79 -,30 1.500-,75 -,25 3.000-,69 -,20 Druckkosten weitere Farben: siehe Onlineshop 1 LESEZEICHEN „BIG BEN“ Setzen Sie ein Zeichen! Mit diesem Lesezeichen ragt Ihr Firmenlogo gut sichtbar aus jedem Buch. Zugleich bieten die Haftnotizen in zwei unterschiedlichen Größen sowie ein Lineal einen praktischen Zusatznutzen für Ihre Kunden. Maße: 21,5 x 6 cm W Werbedruck. Fläche: 40 x 20 mm Preis/Stk.: ab 250 Stück -,19 Werkzeugkosten: Siehe Serviceseiten. 188 643 blau ab -,28 188 651 rot ab -,28 188 660 natur ab -,28 STÜCKAB STÜCK-PREIS 1.DRUCKFARBE 1 -,44 250 -,42 -,19 500 -,40 -,18 1.000 -,36 -,17 2.500 -,34 -,16 5.000 -,30 -,15 10.000 -,28 -,14 Druckkosten weitere Farben: siehe Onlineshop 1 LESEZEICHEN „BIG BEN“ ab 0 28 2 „LIKE“ZETTELHAFTNOTIZab 0 34 2 HAFTNOTIZZETTEL „LIKE“ Ideal, um gute Leistungen hervorzuheben, dem Kollegen zu danken oder positive Gedanken festzuhalten: Haftnotizzettel mit dem vielseitig einsetzbaren „Gefällt-mir-Daumen“. Maße: 8,5 x 10 cm. W Werbedruck. Fläche: 45 x 25 mm Preis/Stk.: ab 300 Stück -,19 Werkzeugkosten: Siehe Serviceseiten. 187 474 weiß ab -,34 187 482 blau ab -,34 187 499 rot ab -,34 187 511 natur ab -,34 STÜCKAB STÜCK-PREIS 1.DRUCKFARBE 1 -,55 300 -,50 -,19 600 -,45 -,18 1.500 -,39 -,17 2.500 -,37 -,16 5.000 -,34 -,15 Druckkosten weitere Farben: siehe Onlineshop * Komplettpreis inklusiv einfarbigem, einseitigen Werbeaufdruck in Standardschrift





































































DRUCK4C Lieferung nur für den gewerblichen Bedarf. Alle Preise zzgl. MwSt.172 | WERBEIDEEN 2 MALSET Ob im Restaurant oder im Wartezimmer – dieses Malset mit Buntstiften und Malbüchlein ist ideal, um Kinder unterwegs zu beschäftigen und eine kleine Freude zu bereiten. Maße: ca. 11 x 8 x 2 cm W Werbedruck. Fläche: auf Box 60 x 30 mm Preis/Stk.: ab 150 Stück -,26 Werkzeugkosten: Siehe Serviceseiten. D Digitaldruck 4c. Fläche: 100 x 40 Preis/Stk.:mmab 150 Stück -,60 Datenhandling: einmalig 29,180 723 ab -,75 STÜCKAB STÜCK-PREIS 1.DRUCKFARBE DIGITAL4C Druckkosten5.0002.5001.00015011,25––1,09-,26-,60300-,99-,23-,55-,95-,19-,45-,85-,18-,40-,75-,16-,35weitereFarben:sieheOnlineshop 2 MALSET ab 0 75 1 BUNTSTIFTE-SET, 1 Set / 20 Päckchen à 6 Stifte 20 Schachteln mit je 6 Buntstiften in einem Set, der perfekte Streuartikel für die kleinen Kunden. Die Vorderseite der Schachtel hat eine große weiße Fläche, ideal für Ihre Werbeanbringung. Maße: 9 x 4,5 x 0,9 cm Hinweis: Nicht für Kinder unter 3 Jahren geeignet. W Werbedruck. Fläche: 45 x 30 mm Preis/Set.: ab 15 Sets 3,95 Werkzeugkosten: Siehe Serviceseiten 090 587 ab 5,95 1 BUNTSTIFT-SET ab 5 95 SETAB PREISSET- DRUCK/SET1.FARBE 1517,256,95 3,95 50 6,50 3,50 150 6,25 3,20 500 5,95 2,95 Druckkosten weitere Farben: siehe Onlineshop

































Bionatic GmbH & Co KG Bevenser Straße 10 28329 Bremen 0421 www.biologischverpacken.degreenbox@bionatic.de24687870 Netto-Preisliste Papier-Tragetaschen, Stand: 28.03.2017 Hach KG, Pfungstadt #19884 Druckkosten pro Stück/Farbe ab: Art Nr Kurzbezeichnung VE Preis pro VE Druckart Druckfläche max. DruckfarbenAnzahl proVorkostenFarbe 500 St 1.000 St 2.500 St 5.000 St 10.000 St DSE02301 Tragetasche 18/21cm braun mit Recyclingpapier 500 25,50 € Siebdruck, einseitig 100 x 130 mm 2 70,00 € 0,30 € 0,29 € 0,26 € 0,24 € 0,22 € DSE02311 Tragetasche 21/25 cm braun mit Recyclingpapier 250 18,50 € Siebdruck, einseitig 130 x 170 mm 2 70,00 € 0,32 € 0,31 € 0,27 € 0,25 € 0,22 € DSE02321 Tragetasche 25/30cm braun mit Recyclingpapier 250 20,50 € Siebdruck, einseitig 170 x 200 mm 2 80,00 € 0,34 € 0,33 € 0,29 € 0,26 € 0,24 € DSE02325 Tragetasche 30/41cm braun mit Recyclingpapier 250 28,90 € Siebdruck, einseitig 170 x 200 mm 2 80,00 € 0,34 € 0,33 € 0,29 € 0,26 € 0,24 € DSE02391 Tragetasche 25x15,5x28,5 cm, breit, braun rec. 250 27,50 € Siebdruck, einseitig 170 x 200 mm 2 80,00 € 0,34 € 0,33 € 0,29 € 0,26 € 0,24 € DSE02331 Tragetasche 18/21cm weiß 500 30,60 € Siebdruck, einseitig 100 x 130 mm 2 70,00 € 0,30 € 0,29 € 0,26 € 0,24 € 0,22 € DSE02341 Tragetasche 21/25cm weiß 250 21,40 € Siebdruck, einseitig 130 x 170 mm 2 70,00 € 0,32 € 0,31 € 0,27 € 0,25 € 0,22 € DSE02351 Tragetasche 25/30cm weiß 250 25,10 € Siebdruck, einseitig 170 x 200 mm 2 80,00 € 0,34 € 0,33 € 0,29 € 0,26 € 0,24 € DSE02355 Tragetasche 30/41cm weiß 250 32,50 € Siebdruck, einseitig 170 x 200 mm 2 80,00 € 0,34 € 0,33 € 0,29 € 0,26 € 0,24 € DSE02395 Tragetasche 25x15,5x28,5 cm, breit, weiß 250 29,40 € Siebdruck, einseitig 170 x 200 mm 2 80,00 € 0,34 € 0,33 € 0,29 € 0,26 € 0,24 € Lieferung: frei Haus innerhalb Deutschlands Lieferzeit: ca. 2-3 Wochen nach finaler Druckfreigabe, unbedruckt ca. 2-3 Tage - Zwischenverkauf vorbehalten Alle o.g. Preisangaben erfolgen freibleibend. Irrtümer und Änderungen bleiben vorbehalten. Mit Erscheinen dieser Preisliste verlieren alle vorherigen Versionen Ihre Gültigkeit. Preise netto zzgl. gesetzl. MwSt. 2 TASCHEPAPIERTRAGEab 0 15 DRUCK4C L ca. 25,5 x 12,5 x 30,5 cm M ca. 22 x 10 x 28 cm 3 INKL.PAPIER-TRAGETASCHE4CDRUCK Eine edle Papiertragetasche ist das beste Aushängeschild für Ihr Unternehmen. Diese Tasche ist aus besonders hochwertigem Kraftpapier (170 g), hat einen kartonverstärkten Rundumschlag und kann vollflächig mit matter Laminierung bedruckt werden. Die Kordelhenkel sind in frei wählbaren Farben verfügbar. Maße: 35 x 9 x 24 cm / 24 x 9 x 35 cm Keine weiteren Werkzeugkosten. Mindestmenge 100 Stück 183 300 hoch ab -,75 183 318 quer ab -,69 STÜCKAB TASCHE HOCH 4C DRUCK TASCHE QUER 4C DRUCK 1003,95 3,85 250 2,45 2,35 500 1,75 1,65 1.500 1,35 1,25 3.000 -,99 -,95 5.000 -,89 -,85 10.000 -,75 -,69 3 INKL.PAPIER-TRAGETASCHE4CDRUCK ab 0 69 Papiertragetasche M 207 608 braun ab -,15 207 616 weiß ab -,15 Papiertragetasche L 172 564 braun ab -,20 172 589 weiß ab -,20 STÜCKAB PREISSTÜCK-M STÜCK-PREISL 1.DRUCKFARBE Druckkosten10.000-,15-,20-,185.000-,16-,22-,201.500-,17-,23-,23500-,18-,24-,241-,24-,30–weitereFarben:sieheOnlineshop 2 PAPIERTRAGETASCHE Der Klassiker unter den Tragetaschen: günstig, stabil, klimaneutral und wiederverwendbar – und damit eine perfekte Werbefläche für Ihr Unternehmen. Mit außen verklebten Papierhenkeln. Braune Taschen aus 80% Recyclingmaterial. Maße: M: 22 x 10 x 28 cm, 70 g/m², L 25,5 x 12,5 x 30,5 cm, 70 g/m², XL* 30 x 12,5 x 40,5 cm, 80 g/m² W Werbedruck. Fläche: M 200 x 150 mm, L 200 x 150 mm, XL* 250 x 200 mm Preis/Stk.: ab 500 Stück -,24 Werkzeugkosten: Siehe Serviceseiten. Mehrfarbiger Druck auf Anfrage. * Papiertragetasche XL braun und weiß auf Anfrage 173WERBEIDEEN | 1 NOTIZBUCH A6/A5 Für kluge Gedanken, Notizen, Skizzen & Co. – klassisches schwarzes Notizbuch aus Kunstleder mit farbigem Gummiband, Lesezeichenband und Farbschnitt passend zum Gummiband. 80 cremefarbene Blankoseiten. Maße: 8,8 x 14,5 x 1,3 cm (A6) bzw. 14,7 x 21 x 1,3 cm (A5) W Werbedruck. Fläche: 50 x 25 mm (A6) bzw. 80 x 30 mm (A5) Preis/Stk.: ab 70 Stück -,55 Werkzeugkosten: Siehe Serviceseiten. D Digitaldruck 4c. Fläche: 50 x 25 mm (A6) bzw. 80 x 30 mm (A5) Preis/Stk.: ab 70 Stück 1,20 Datenhandling: einmalig 29,STÜCKAB PREISA6 PREISA5 WERBE-DRUCK DIGITAL4C Druckkosten1.000-,951,99-,35-,851001,302,19-,501,15701,452,35-,551,2011,552,45––2501,152,09-,451,055001,052,05-,40-,95weitereFarben:sieheOnlineshopDRUCK4C 1 NOTIZBUCH A6/A5 ab 0 95 172 958 A6 blau ab -,95 172 974 A6 rot ab -,95 172 999 A6 grün ab -,95 172 940 A5 blau ab 1,99 172 966 A5 rot ab 1,99 172 982 A5 grün ab 1,99













































































































































































DRUCK4C Mit AussensensorFunkLieferung nur für den gewerblichen Bedarf. Alle Preise zzgl. MwSt.174 | WERBEIDEEN WERBENGENAU AUF EINENBLICK 2 REEVES-SANSOLARTASCHENRECHNERLORENZO ab 5 95 1 BEL-AIRMITFUNK-THERMO-HYGROMETERLÜFTUNGSEMPFEHLUNG 29 95 3 MINI-LOCHER „PAGE“ Dieser schlanke Kunststoff-Locher mit Lineal macht aus jedem Ordner ein mobiles Büro. Dank seiner flachen Form lässt er sich selbst ganz einfach einheften und sorgt dafür, sodass Sie auch unterwegs Ihre Papiere jederzeit abheften können. Maße: 13 x 6,8 x 0,5 cm W Werbedruck. Fläche: 50 x 15 mm Preis/Stk.: ab 250 Stück -,24 Werkzeugkosten: siehe Serviceseiten. 150 684 blau ab -,39 150 692 rot ab -,39 150 705 weiß ab -,39 STÜCKAB STÜCK-PREIS 1.DRUCKFARBE 1 -,59 250 -,51 -,24 500 -,49 -,20 1.500-,47 -,19 5.000-,39 -,17 Druckkosten weitere Farben: siehe Onlineshop 3 „PAGE“MINI-LOCHER ab 0 39 2 REEVES-SANSOLARTASCHENRECHNERLORENZO
Außentemperatur und Luftfeuchtigkeit erfolgt über einen externen Sender. Die Innentemperatur und Luftfeuchtigkeit wird mit farbigen Komfortzonen für ein gesundes Raumklima angezeigt. Höchst- und Tiefstwerte Funktion. Maße: 9,5 x 2 x 15,8 cm 214 131 29,95
Farbe. Dieser Tischrechner ist ein schickes und nützliches Schreibtisch Accessoire mit prominenter Werbefläche. Batterien inklusive.. Maße: 19,3 x 10,5 x 3,3cm W Werbedruck. Fläche: 70 x 20 mm Preis/Stk.: ab 12 Stück 2,50 Werkzeugkosten: siehe Serviceseiten. D Digitaldruck 4c. Fläche: 90 x 20 Preis/Stk.:mmab 12 Stück 3,50 Datenhandling: einmalig 29,213 149 rot ab 5,95 213 157 weiß ab 5,95 213 165 schwarz ab 5,95 STÜCKAB STÜCKPREIS 1.DRUCKFARBE DIGITAL4C Druckkosten5005,95-,601,202506,95-,851,501007,501,251,95408,101,952,50128,8519,65––2,503,50weitereFarben:sieheOnlineshop 1 BEL-AIRMITFUNK-THERMO-HYGROMETERLÜFTUNGSEMPFEHLUNG Nie wieder dicke Luft! Dank gleichzeitiger Überprüfung von Raumklima und Außenklima zeigt der Funk-ThermoHygrometer Lüftungsempfehlungen, wenn Öffnen oder Schließen der Fenster das Raumklima verbessert werden soll. Die kabellose Übertragung
Ästhetischer schlanker Solartaschenrechner mit flachen Drucktasten in der jeweiligen der
























































































STÜCK10 befüllt ca. 20-30 Ballons 1.000 017LUFTBALLONS378 179.-WERBETIPP* * Komplettpreis inklusiv einfarbigem, einseitigen Werbeaufdruck in Standardschrift 1 LUFTBALLON Zur Schaufensterdekoration. Luftballons aus reinem Kautschuk. Inklusive Werbedruck Maße: Ø ca. 30 cm W Werbedruck. Fläche: 140 x 90 Mindestabnahmemengemm 1.000 Stück. Lieferung erfolgt bunt gemischt. Zuzüglich Werkzeugkosten: 45,Lieferzeit für Werbedruck 15 Arbeitstage. 093 364 inkl. Werbedruckeinfarbigem ab -,09 2 ÖKO STÄBE,LUFTBALLON-TRAGE1 Set / 100 Stk. Ohne Abb. Stabile Tragestäbe aus Öko-Kunststoff. Maße: je 39 cm lang 095 671 9,95 1 LUFTBALLON ab0 09 4 HELIUM-BALLONGAS 59.STÜCKAB INKL.STÜCKPREIS1CDRUCK 1.000 -,14 3.000 -,13 10.000 -,11 20.000 -,09 Druckkosten weitere Farben: siehe Onlineshop 5 MITMASSAGE-BÄLLE„STACHELN“ 1 Set / 10 Stück Erholsam! Die biegsamen Spitzen der Gummibälle massieren wohltuend Hände. Hinweis: Lieferung erfolgt bunt gemischt. Maße: Ø 5,3 cm 112 362 12,95 5 MITMASSAGE-BÄLLE„STACHELN“ 12 95 3 LUFTBALLONS Ohne Werbeaufdruck 1 Set / 100 Stk. Maße Luftballon: ca. Ø 30 cm aufgepumpt. Lieferung erfolgt bunt gemischt in der Kunststoffdose. 098 286 9,95 4 HELIUM BALLONGAS, 2,2 L Zum Befüllen von ca. 20-30 Ballons. 127 091 59,3 OHNELUFTBALLONWERBUNG 9 95 175WERBEIDEEN |





































BrilleputzenPC-Putztuch Lieferung nur für den gewerblichen Bedarf. Alle Preise zzgl. MwSt. 99
Bei diesem modernen Druckverfahren bleibt die schonende Reinigungskraft auf beiden Tuchseiten erhalten. Die Druckkosten für einen 4-farbigen Aufdruck sind im Stückpreis enthalten. Datenhandling: einmalig 29,081 914 Tuch ohne Werbeaufdruck 1,29 081 906 Tuch inkl. 4-fbg. Aufdruck ab 1,45 2 MOUSE-PAD, INKL. 4C DRUCK Mouse-Pad mit riesiger Druckfläche, schon in kleinen Stückzahlen (ab 40 Stk.)
lieferbar. Material: Moosgummi mit 100% Polyester-Textil-Oberfläche. Maße: 190 x 230 mm, 3 mm dick! Hinweis: Druckkosten für einen 4-farbigen Werbedruck inklusive. Auf Wunsch auch mit Kalendarium ohne Mehrpreis, bitte bei Bestellung separat angeben. Druckfl äche: 190 x 230 mm Datenhandling: einmalig 29,290 205 ab 2,99 1 MICROFASERTUCH ab 1 29 2 MOUSEPAD INKL. 4C-DRUCK ab 2 99 MENGE STÜCKPREIS INKL. 4C 40 3,05 100 2,55 250 1,95 500 1,65 1.000 1,45 MENGE STÜCKPREIS INKL. 4C 40 4,45 250 3,95 500 3,45 1.500 2,99 MENGE STÜCKPREIS INKL. 4C 24 4,65 48 4,55 96 4,35 192 3,99 288 3,89 576 3,69 1.152 3,29 2.304 2,99 3 GLASBECHER, INKL. 4C DRUCK Breiter, stabiler Becher aus weißem gefrostetem Glas. Maße: H ca. 9,5 cm, Ø 8 cm, Inhalt ca. 0,25 l. Druckfläche: 180 x 80 mm im Rundumdruckverfahren. Hinweis : Die Druckkosten für einen 4-farbigen Aufdruck sind im Stückpreis Mindestmengeenthalten. 24 Stück. Datenhandling: einmalig 29,179 512 ab 2,99 MINI MENGE ZUM MINI PREIS
1 MICROFASERTUCH, WEISS Ideal zur Reinigung von empfindlichen Oberflächen.Das Tuch ist äußerst leistungsfähig dank Microfaserstruktur. Verwendung sowohl trocken als auch „nebelfeucht“ möglich. Reinigungsfunktion auf beiden Tuchseiten. Garantiert streifenfreie und flusenfreie Reinigung ohne Kratzer. Lieferung erfolgt in einer Material:wiederverschließbaresEinzelverpackung,Klarsichtetui.100%Microfaser. Maße: 18 x 18 cm Hinweis: Die Werbeanbringung erfolgt ab einer Stückzahl von 40 Tüchern durch einseitigen Digitaldruck.
176 | WERBEIDEEN 3 GLASBECHER INKL. 4C-DRUCK ab 2

























SIEWIRGESTALTENDRUCKEN 177WERBEIDEEN |
2
KERAMIK-TASSE „STEFFI“ inklusive 4c-Druck Auf dieser klassischen weißen Tasse kommt Ihre Botschaft besonders gut zur Geltung – in höchster fotorealistischer Druckqualität. Inhalt: 290 ml Maße: ca. Ø 7 x 10,5 cm Druckfl äche: 170 x 105 mm im Rundumdruckverfahren. Hinweis: Die Druckkosten für einen 4-farbigen Aufdruck sind im Stückpreis Mindestmengeenthalten. 24 Stk.
3 KERAMIKBECHER inklusive 4c-Druck Ideal für kleine Stückzahlen ab 24 Bechern, gut geeignet für Vereine, Schulen oder Handwerker. Fotos und farbige Logos können in 1-A Druckqualität im Rundumdruck aufgebracht werden. 100% spülmaschinenfest für garantierte 2000 Spülgänge. Inhalt: 330 ml Maße: ca. Ø 8 x 9,5 cm Druckfl äche: 95 x 210 mm Hinweis: Die Druckkosten für einen 4-farbigen Aufdruck sind im Stückpreis Mindestmengeenthalten. 24 Stk. Datenhandling: einmalig 29,-
Datenhandling: einmalig 29,132 871 ab 3,85
288 518 ab 2,99 MENGE STÜCKPREIS INKL. 4C 24 5,35 48 5,15 96 5,05 192 4,90 288 4,55 576 4,15 1.152 3,95 2.304 3,85 MENGE STÜCKPREISINKL.4C 24 4,99 48 4,79 96 4,69 192 4,29 288 3,99 576 3,69 1.152 3,19 2.304 2,99 2 „STEFFI“KERAMIKTASSE INKL. 4C-DRUCK ab 3 85 3 KERAMIKBECHER INKL. 4C-DRUCK ab 2 99 1 TRINKFLASCHE ALUMINIUM 750 ml, WEISS inkl. 4c-Sublimationsdruck Diese Trinkflasche aus Aluminium ist perfekt für eine besonders großflächige Veredelung im Fotodruck. Dank Silikonring ist der Verschluss auslaufsicher. Mit dem Karabinerhaken kann die Flasche auch unterwegs gut an Rucksack & Co. befestigt werden. Inhalt: 750 ml Maße: Ø 7,3 x 24,5 cm SB Sublimationsdruck 4C. Fläche: 100 x 80 mm im Rundumdruckverfahren. Hinweis: Die Druckkosten für einen 4-farbigen Aufdruck sind im Stückpreis Mindestmengeenthalten. 20 Stk. Datenhandling: einmalig 29,205 471 ab 3,95 MENGE STÜCKPREISINKL.4C 20 6,15 50 5,95 100 5,45 250 5,25 500 4,45 1.000 3,95 1 TRINKFLASCHE INKL. 4C-DRUCK ab 3 95















DRUCK4C 2 „POCKET“PFLASTERBOX ab 0 20 immer dabei, wenn man‘s braucht 3 SEIFENBLÄTTER-DOSE Der praktische Werbeartikel für unterwegs: Seifendose mit 15 Seifenblättchen zur Einzelentnahme. Maße: Dose ca. 66 x 12 mm Inhalt: 15 Blättchen W Werbedruck. Fläche: 40 x 40 mm Preis/Stk.: ab 100 Stück -,37 Werkzeugkosten: Siehe Serviceseiten. D Digitaldruck 4c. Fläche: 40 x 40 Preis/Stk.:mmab 100 Stück -,85 Datenhandling: einmalig 29,202 071 blau ab -,69 214 140 rot ab -,69 214 158 transparent ab -,69 STÜCKAB STÜCK-PREIS 1.DRUCKFARBE DIGITAL4C Druckkosten2.0001.000-,79500250-,9910011,19–1,09-,37-,85-,32-,75-,89-,27-,65-,22-,55-,69-,15-,40weitereFarben:sieheOnlineshop 3 DOSESEIFENBLÄTTERab 0 69 DRUCK4C Lieferung nur für den gewerblichen Bedarf. Alle Preise zzgl. MwSt.178 | WERBEIDEEN 1 ERSTE HILFE BOX ab 2 50 1 ERSTE HILFE BOX Auf einem Erste-Hilfe-Set platzieren Sie Ihre Werbung wenn Hilfe naht. Diese milchig-durchsichtige Box enthält alles, was bei der Versorgung von kleinen Wunden & Co. benötigt wird: 1 Folienverband, 1 Schwamm aus NonWoven, 5 sterile Bandagen, 1 elastische Kompressionsbandage, 4 alkoholische Desinfektionstücher, 2 Reinigungstücher, 1 Wundkompresse sowie 1 Schere. Maße: 16,2 x 7,9 x 3,8 cm W Werbedruck. Fläche: Auf Vorderseite 40 x 20 mm, Rückseite 70 x 30 mm. Preis/Stk.: ab 30 Stück 1,20 Werkzeugkosten: Siehe Serviceseiten. 191 908 ab 2,50 STÜCKAB STÜCK-PREIS 1.DRUCKFARBE 1 3,95 30 3,85 1,20 60 3,65 1,150 3,35 -,90 500 2,95 -,70 1.000 2,50 -,50 Druckkosten weitere Farben: siehe Onlineshop 2 PFLASTERBOX „POCKET“ Ob für kleine Schnittwunden oder das aufgeschürfte Knie: Die transparent gefrostete Pflasterbox aus Kunststoff sollte bei keinem Ausflug fehlen. Inkl. 5 Pflaster. Maße: 10 x 4 x 1 cm W Werbedruck. Fläche: 50 x 15 Preis/Stk.:mmab 500 Stück -,24 Werkzeugkosten: Siehe Serviceseiten. D Digitaldruck 4c. Fläche: 80 x 30 Preis/Stk.:mmab 500 Stück -,60 Datenhandling: einmalig 29,183 367 weiß ab -,20 183 375 blau ab -,20 183 383 rot ab -,20 183 391 grün ab -,20 STÜCKAB STÜCK-PREIS 1.DRUCKFARBE DIGITAL4C 10.0001.0005001-,40––-,35-,24-,60-,32-,21-,502.500-,28-,18-,405.000-,24-,15-,30-,20-,12-,25DruckkostenweitereFarben:sieheOnlineshop
























































































































1 SET PFLASTERMÄPPCHEN ab 199.DRUCK4C 120 101101PFLASTERBOXEN497blau501weiß 119.-WERBETIPP* 179WERBEIDEEN | WERBEN UND GUTES TUN 3 MASKEEMERGENCY ab 0 95 1 PFLASTERBOX „CARE CARD“ Immer griffbereit. 10 Pflasterstrips in hochwertiger Kunststoffbox. In klassisch weißer Box oder modern frosty transparent. Deckel mit sicherem Schnappverschluss. Große Werbefläche. Maße: Box 8 x 3,5 x 1,5 cm W Werbedruck. Fläche: 50 x 16 mm Preis/Stk.: ab 200 Stück -,16 Werkzeugkosten: Siehe Serviceseiten D Digitaldruck 4c. Fläche: 55 x 23 Preis/Stk.:mmab 200 Stück -,40 Datenhandling: einmalig 29,281 979 weiß vollfarben ab -,49 281 987 blau frosty ab -,49 281 995 rot frosty ab -,49 STÜCKAB STÜCKPREIS 1.DRUCKFARBE DIGITAL4C Druckkosten1.000-,57-,15-,35200-,60-,16-,401-,66–2.500-,54,-14-,305.000-,49-,13-,26weitereFarben:sieheOnlineshop SETAB INKL.4CDRUCK 1 215,5 209,10 199,2 „MAILCARE“PFLASTERMÄPPCHEN 400 Stück inkl. 4-farbigem Werbedruck 400 Stück nach Ihrer Vorlage bis maximal 4-farbig bedruckte Mäppchen inkl. 4 einzeln eingesiegelten Pflasterstrips. Die Grundfarbe des Mäppchens ist frei wählbar. Ohne Angabe einer Farbe drucken wir auf weißem Karton. Druckfl äche: 80 x 30 mm Einmalige Werkzeugkosten: 58,099 457 ab 199,4 ERSTE HILFE SET MIT KARABINER Ideal für Reisen, Outdoor-Abenteuer und Ausflüge: Das handliche Notfallset im Polyester-Etui kann dank Karabinerhaken ganz einfach an der Gürtelschlaufe oder dem Rucksack befestigt werden und enthält neben 5 Pflastern und einer Bandage auch 3 Baumwolltupfer, Schere und ein feuchtes Tuch. Maße: 10 x 7 x 2 cm SP Spezialsiebdruck. Fläche: 60 x 35 Preis/Stk.:mmab 50 Stück -,80 Werkzeugkosten: Siehe Serviceseiten 183 885 weiß ab 1,99 183 893 rot ab 1,99 183 932 grün ab 1,99 STÜCKAB STÜCK-PREIS 1.DRUCKFARBE 5012,992,79 -,80 100 2,69 -,75 250 2,59 -,70 1.000 2,29 -,60 2.500 1,99 -,50 Druckkosten weitere Farben: siehe Onlineshop 1 „CAREPFLASTERBOXCARD“ ab 0 49 4 ERSTE HILFE SET MIT KARABINER ab 1 99 3 EMERGENCY MASKE Die Beatmungsmaske ‚Emergency‘ aus Kunststoff wird in einer kleinen Polyestertasche mit Klettverschluss und Schlüsselring zusammengefaltet geliefert. Das aufgenähte weiße Label dient als Druckfläche. Maße: 5,5 x 5,0 x 2,0 cm W Werbedruck. Fläche: 30 x 5 mm Preis/Stk.: ab 80 Stück -,55 Werkzeugkosten: Siehe Serviceseiten. 201 749 ab -,95 STÜCKAB STÜCK-PREIS 1.DRUCKFARBE 1 1,75 80 1,55 -,55 1501,35 -,50 300 1,25 -,45 7001,15 -,40 1.500 1,05 -,35 3.000-,95 -,25 Druckkosten weitere Farben: siehe Onlineshop MADE GERMANYIN * Komplettpreis inklusiv einfarbigem, einseitigen Werbeaufdruck in Standardschrift






























































siehe
4 WARNWESTE nach DIN „ EN ISO 20471“ Die sollte jeder im Auto haben, am besten gleich für alle Insassen. Im Falle eines Unfalls kann eine solche Weste Leben retten. Seit Juli 2014 Pflicht in allen PKW und LKW. Warnwesten aus strapazierfähigem Nylon. 2 Reflektorstreifen vorne und hinten. Mit Klettverschluss. Etui mit Trageschlaufe. Maße: Einheitsgröße XL, gefaltet im Etui ca. 15 x 11 x 3 cm Lieferung: im handlichen Nylon-Etui. SP Spezialsiebdruck. Fläche: Etui: 100 x 50 mm Preis/Stk.: ab 40 Stück -,90 SP Spezialsiebdruck. Fläche: auf Rücken der Weste, 250 x 250 mm Preis/Stk.: ab 40 Stück -,90 Werkzeugkosten: Siehe Serviceseite. Hinweis: Mischaufträge in gelb und orange sind bei gleicher Druckfarbe möglich. 012 200 gelb ab 2,29 129 626 orange ab 2,29 STÜCK-PREIS 1.DRUCKFARBE -,95 -,85 -,75 -,70 -,55 Farben: siehe Onlineshop WARNWESTEKINDERab 1 95 3 KINDER-WARNWESTE nach DIN „EN 340“ Die Sicherheit unserer Kinder geht über alles! Ideal für den Weg zu Kindergarten, Schule oder nachmittags zum Spielplatz. Leichte Nylonweste mit 2 umlaufenden Reflektionsstreifen nach EN 340. Durch 2 Klettverschlüsse einfach verschließbar. Einheitsgröße Maße: ca. 50 x 50 cm SP Spezialsiebdruck. Fläche: auf die linke Brustseite, ca. 80 x 80 mm Preis/Stk.: ab 50 Stück -,95 Werkzeugkosten: Siehe Serviceseiten 110 432 ab 1,95 STÜCKAB STÜCK-PREIS 1.DRUCKFARBE 40 3,09 -,90 2502,69 -,85 5002,59 -,80 1.0002,49 -,70 -,60 Farben: Onlineshop 1 FUSSGÄNGER-REFLEKTOR „BÄR“ An der Kleidung befestigt, ist er für Autofahrer aus bis zu 150 Meter Entfernung erkennbar. Nur bunt gemischt lieferbar. Mit Sicherheitsnadel und Faden. Maße: ca. 7 x 5 x 0,5 cm W Werbedruck.
1.0002,25
5002,55
502,9513,25
2.0002,29
Fläche: 25 x 25 mm Preis/Stk.: ab 240 Stück -,22 Werkzeugkosten: 55,-/Farbe. 024 073 für Werbedruck ab -,69 285 888 ohne Druck ab -,69 STÜCKAB STÜCK-PREIS 1.DRUCKFARBE 24011,291,09 -,22 960 -,99 -,20 1.920 -,79 -,19 3.840 -,69 -,18 Druckkosten weitere Farben: siehe Onlineshop 240 018buntREFLEKTORENFUSSGÄNGER-gemischt645 329.-WERBETIPP* 1 „BÄR“REFLEKTORFUSSGÄNGERab 0 69 einfach abziehen fluoreszierend STÜCK25 2 REFLEKTOR STICKER GESICHTER 25 Stück Ein Lächeln für mehr Sicherheit. Die leuchtenden fluoreszierenden Smileys mit ihren lustigen Gesichtern sind ideal, um sie an Schulranzen, Kinderrucksäcken, Regenjacken & Co. zu platzieren. Damit sorgen Sie für mehr Sichtbarkeit in der Dunkelheit. Maße: je Ø 5 cm 188 024 9,95 2 REFLEKTOR STICKER GESICHTER 9 95
4 WARNWESTE ab2 29 3
STÜCKAB
Druckkosten weitere
2.5001,95
180 | WERBEIDEEN
Druckkosten weitere
SicherheitfürGroßundKlein Lieferung nur für den gewerblichen Bedarf. Alle Preise zzgl. MwSt.
1 3,39
2502,75
































































Werbeflächegroße 100 102AUSWEISTASCHEN607 255.-WERBETIPP* * Komplettpreis inklusiv einfarbigem, einseitigen Werbeaufdruck in Standardschrift 100 141SCHLÜSSELETUIS403 219.-WERBETIPP* 2 EISKRATZER Damit Ihre Kunden auch bei eisigen Temperaturen nicht den Durchblick verlieren empfehlen wir Ihnen diese gefrosteten Eiskratzer mit extra großer Werbefl äche. W Werbedruck. Fläche: 60 x 35 mm Preis/Stk.: ab 180 Stück -,20 Werkzeugkosten: Siehe Serviceseiten. 177 728 blau ab -,49 177 736 rot ab -,49 177 744 orange ab -,49 177 752 weiß ab -,49 STÜCKAB STÜCK-PREIS 1.DRUCKFARBE 1 180-,67-,75 -,20 350-,61 -,19 1.000-,54 -,18 2.500-,49 -,16 Druckkosten weitere Farben: siehe Onlineshop 2 EISKRATZER ab 0 49 181WERBEIDEEN | 3 AUSWEISTASCHE ab 1 29 3 AUSWEISTASCHE Geprägte „Steppnähte“. Große Werbefl äche. Maße: geschlossen 12 x 8,7 x 0,6 cm W Werbedruck. Fläche: 65 x 30 mm Preis/Stk.: ab 100 Stück -,35 Werkzeugkosten: Siehe Serviceseiten. 023 407 ab 1,29 STÜCKAB STÜCKPREIS 1.DRUCKFARBE 1 2,15 100 1,95 -,35 250 1,85 -,30 1.0001,55 -,28 2.0001,29 -,20 Druckkosten weitere Farben: siehe Onlineshop STÜCKAB STÜCK-PREIS GRAVURLASER1 4,99 25 4,59 1,25 1004,19 1,10 2503,99 -,95 1.0003,69 -,85 4 SCHUTZENGEL-ZETTELHALTER Ob im Auto, im Büro oder in der Küche: Der Schutzengel findet überall seinen Platz. Ein fach die Klebefolie an der Metallplatte entfernen und auf das Armaturenbrett oder den ComputerMonitor anbringen. Schon ist der Notizzettelhalter mit Schutzfunktion fertig. Ideal für kleine Notizen, Parkscheine etc. Lieferung im Geschenkkarton. Material: Edelstahl Maße: ca. 3,5 x 3 x 3 cm L Lasergravur. Fläche: auf die Metallplatte, 15 x 10 mm Preis/Stk.: ab 25 Stück 1,25 Werkzeugkosten: Siehe Serviceseiten 094 679 ab 3,69 4 ZETTELHALTERSCHUTZENGEL ab 3 69 1 ECHTLEDER-SCHLÜSSELETUI Mit 2 Reißverschlussfächern. Aus schwarzem Leder, innen mit Stoff. Maße: ca. 10 x 7 cm W Werbedruck. Fläche: 65 x 15 mm Preis/Stk.: ab 100 Stück -,30 Werkzeugkosten: Siehe Serviceseiten. 031 089 ab 1,09 STÜCKAB STÜCKPREIS 1.DRUCKFARBE 1 1001,691,89 -,30 2501,49 -,28 5001,39 -,25 1.0001,19 -,22 2.0001,09 -,22 Druckkosten weitere Farben: siehe Onlineshop 1 SCHLÜSSELETUIECHTLEDER ab 1 09



























































Mit Einkaufswagenchips 120 014PARKSCHEIBEN377 195.-WERBETIPP* 500 SCHEIBENPARK- / REISE102RECHNER060 229.-WERBETIPP* MADE GERMANYGERMANYINMADEINDRUCK4C 1 PARKSCHEIBE MIT LADEZEIT-ANZEIGEE-AUTO Doppelseitige Parkscheibe zum Einstellen der Uhrzeit für die BatterieLadedauer oder für die blaue Parkzone. Parkscheibe entspricht § 42 StVO, mit 1/2 Std.-Einteilung. Made in Germany Maße: ca. 15 x 11 cm W Werbedruck. Fläche: 70 x 30 Preis/Stk.:mmab 250 Stück -,18 Werkzeugkosten: Siehe Serviceseiten. 220 470 ab -,29 STÜCKAB STÜCKPREIS 1.DRUCKFARBE 1 -,50 250 -,46 -,18 500 -,44 -,17 1.000 -,41 -,16 2.500 -,39 -,15 5.000 -,34 -,14 10.000 -,29 -,12 Druckkosten weitere Farben: siehe Onlineshop 1 PARKSCHEIBE MIT E-AUTO ANZEIGELADEZEITab 0 29 MADE GERMANYIN Lieferung nur für den gewerblichen Bedarf. Alle Preise zzgl. MwSt.182 | WERBEIDEEN STÜCKAB STÜCKPREIS 1.DRUCKFARBE DIGITAL4C Druckkosten5.000-,89-,15-,302.500-,95-,20-,451.000-,99-,25-,555001,10-,28-,601001,15-,30-,7011,25–weitereFarben:sieheOnlineshop 2 PARKSCHEIBE Parkscheibe mit Scheiben-Gummiabzieher und Eiskratzer §41 der StVO. Inkl. 3 Einkaufswagen-Chips. Kunststoff. Maße: 15,5 x 12 x 0,5 cm W Werbedruck. Fläche: 75 x 70 mm Preis/Stk.: ab 100 Stück -,30 Werkzeugkosten: siehe Serviceseiten. D Digitaldruck 4c. Fläche: 85 x 70 Preis/Stk.:mmab 100 Stück -,70 Datenhandling: 29,034 723 ab -,89 3 PARKSCHEIBE REISERECHNERUND Parkscheibe aus Papier nach §41 der StVO. Rückseite mit praktischem Reise-Rechner für Kraftstoffverbrauch pro 100 km und Fahrtkosten. Maße: 15 x 11 cm W Werbedruck. Fläche: Rückseite 75 x 25 mm Preis/Stk.: ab 500 Stück -,14 Werkzeugkosten: Siehe Serviceseiten. 041 319 ab -,16 5M STÜCKAB STÜCK-PREIS 1.DRUCKFARBE 1 500-,27-,32 -,14 1.500-,22 -,13 5.000-,19 -,12 10.000-,16 -,10 Druckkosten weitere Farben: siehe Onlineshop 2 PARKSCHEIBE ab 0 89 3 PARKSCHEIBE REISERECHNERUND ab 0 16












































Innenseite sowohl einen
zum
Dieser Kronkorken im XL-Format hat auf seiner Flaschenöffner Aufhebeln als auch einen zum Aufdrehen. te Magnete sorgen der Kronkorken griffbereit an Kühlschrank & Co. befestigt werden kann und dabei Ihre Werbebotschaft bestens zur Geltung kommt. Maße: Ø 7,6 x 1,7 cm W Werbedruck. Fläche: Ø 45 mm Preis/Stk.: ab 150 Stück -,22 Werkzeugkosten: Siehe Serviceseiten. D Digitaldruck 4c. Fläche: Ø 45 mm Preis/Stk.: ab 150 Stück -,55 Datenhandling: einmalig 29,190 261 ab -,49 3 UNTERSETZER MIT FLASCHENÖFFNER „TOGETHER“
am Boden hat nicht nur einen integrierten Flaschenöffner, sondern bietet auch jede Menge Platz für Ihre Werbebotschaft. Maße: 8,2 x 8,2 cm W Werbedruck. Fläche: 70 x 30 mm Preis/Stk.: ab 300 Stück -,16 Werkzeugkosten: Siehe Serviceseiten. D Digitaldruck 4c. Fläche: 70 x 30 Preis/Stk.:mmab 300 Stück -,36 Datenhandling: einmalig 29,177 283 weiß ab -,28 177 291 schwarz ab -,28 177 306 blau ab -,28 177 314 rot ab -,28 177 322 apfelgrün ab -,28 STÜCKAB STÜCK-PREIS 1.DRUCKFARBE DIGITAL4C 3001-,45–-,39-,16 -,36 1.500 -,36 -,15 -,34 5.000 -,32 -,14 -,32 7.500 -,28 -,13 -,28 Druckkosten weitere Farben: siehe Onlineshop 3 UNTERSETZER „TOGETHER“FLASCHENÖFFNERMIT ab 0 28 200 114114KAPSELHEBER895blau900rot 159.-WERBETIPP* 2 KAPSELHEBER Kapsel- und Schraubverschlussöffner, gleichzeitig Flaschenverschluss. Kunst stoff. In 4 Farben. Maße: 9,5 x 4,2 x 1 cm W Werbedruck. Fläche: 40 x 25 mm Preis/Stk.: ab 300 Stück -,16 Werkzeugkosten: Siehe Serviceseiten. D Digitaldruck 4c. Fläche: 38 x 33 Preis/Stk.:mmab 300 Stück -,35 Datenhandling: einmalig 29,023 101 blau ab -,36 023 110 rot ab -,36 023 128 weiß ab -,36 023 136 gelb ab -,36 STÜCKAB STÜCK-PREIS 1.DRUCKFARBE DIGITAL4C Druckkosten2.5001.0003001-,55––-,50-,16-,35-,42-,15-,32-,38-,14-,305.000-,36-,12-,26weitereFarben:sieheOnlineshop DRUCK4C 2 KAPSELHEBER ab 0 36 * Komplettpreis inklusiv einfarbigem, einseitigen Werbeaufdruck in Standardschrift
Die perfekte Kombination für gesellige Runden! Der Untersetzer mit Anti-Rutsch-Beschichtung
dafür, dass
STÜCKAB STÜCK-PREIS 1.DRUCKFARBE DIGITAL4C Druckkosten10.0005.0002.5001.0004001501-,89–-,80-,22-,55-,70-,20-,50-,65-,19-,45-,55-,17-,40-,52-,16-,37-,49-,14-,30weitereFarben:sieheOnlineshop 1 „SAKUMONO“FLASCHENÖFFNER ab 0 49
ÖFFNET NEUE PERSPEKTIVEN KronkorkenImgriffigenDesign Zwei in Einem 183WERBEIDEEN | DRUCK4C 1 „SAKUMONO“FLASCHENÖFFNER
Integrier-



























































































entsperren..Einkaufswagen ...und Caddy Key wieder herausziehen DRUCKDRUCK4C4CDRUCK4C 500 bunt062WAGEN-CHIPSEINKAUFS-885gemischt 205.-WERBETIPP* Lieferung nur für den gewerblichen Bedarf. Alle Preise zzgl. MwSt.184 | WERBEIDEEN GEHEN SIE MIT IHRER WERBUNG AUF EINKAUFSTOUR 1 METALL WAGEN-CHIPEINKAUFSab 0 49 1 METALL EINKAUFSWAGENCHIP Gehen Sie mit Ihren Kunden auf Einkaufstour. Dieser praktische Chip ersetzt nicht nur die Münze im Einkaufswagen, sondern überzeugt auch als edler Hingucker am Schlüsselbund. Maße: Ø 2,2 cm Lieferzeit: ca. 3 Wochen. D Digitaldruck 4c. Fläche: Ø 22 mm Preis/Stk.: ab 250 Stück -,25 Datenhandling: einmalig 29,Ohne Druck 181 210 weiß ab -,49 181 228 blau ab -,49 181 236 gelb ab -,49 181 244 rot ab -,49 Für Druck 181 172 weiß ab -,49 181 189 blau ab -,49 181 197 gelb ab -,49 181 201 rot ab -,49 STÜCKAB STÜCK-PREIS DIGITAL4C 1 -,89 250 -,79 -,25 500 -,69 -,22 1.000 -,59 -,20 2.500 -,55 -,17 5.000 -,49 -,15 3 „CADDYEINKAUFSWAGENAUSLÖSERKEY“
oft standen Sie schon am Einkaufswagen und hatten weder passendes Kleingeld noch einen Chip dabei? Das ist jetzt vorbei. Denn dieser Schlüssel-anhänger löst Einkaufswagen aus, ohne dass er im Einkaufswagen stecken bleiben muss. Einfach kurz in den Einkaufswagen stecken und sofort wieder herausziehen. Maße: 7 x 2,8 cm W Werbedruck. Fläche: 35 x 15 mm Preis/Stk.: ab 300 Stück -,18 Werkzeugkosten: Siehe Serviceseiten. D Digitaldruck 4c. Fläche: 35 x 15 mm Preis/Stk.: ab 300 Stück -,45 Datenhandling: einmalig 29,164 271 weiß ab -,24 164 280 blau ab -,24 164 298 rot ab -,24 164 302 grün ab -,24 3 „CADDYAUSLÖSEREINKAUFSWAGEN-KEY“ ab 0 24 STÜCKAB STÜCK-PREIS 1.DRUCKFARBE DIGITAL4C Druckkosten10.0003.0001.5008003001-,39–-,34-,18-,45-,32-,16-,40-,29-,15-,35-,26-,14-,30-,24-,12-,25weitereFarben:sieheOnlineshop 2 EINKAUFSWAGEN-CHIP Chip und Halterung aus Kunststoff. Lieferung ohne Schlüsselring. Maße: 5,6 x 3 x 0,3 cm W Werbedruck. Fläche: 37 x 22 mm Preis/Stk.: ab 500 Stück -,14 Werkzeugkosten: Siehe Serviceseiten. D Digitaldruck 4c. Fläche: 43 x 26 mm Preis/Stk.: ab 500 Stück -,35 Datenhandling: einmalig 29,100 509 rot ab -,17 100 517 weiß ab -,17 100 525 blau ab -,17 STÜCKAB STÜCK-PREIS 1.DRUCKFARBE DIGITAL4C Druckkosten5.0002.5001.0005001-,26–-,24-,14-,35-,22-,13-,30-,19-,12-,25-,17-,11-,22weitereFarben:sieheOnlineshop 2 CHIPWAGEN-EINKAUFSab 0 17
Wie



















































5.000
2 HOLZ-SCHLÜSSELANHÄNGER „WOODY“ Handschmeichler und stilvoller Schlüsselanhänger zugleich. Die natürliche Maserung des Holzes sorgt für einen besonders natürlichen Look. Maße: 5,8 x 3,7 x 0,8 cm W Werbedruck. Fläche: 30 x 15 mm Preis/Stk.: ab 300 Stück -,15 L Lasergravur. Preis/Stk.: Stück -,33 Werkzeugkosten: Siehe -,39 STÜCKAB STÜCK-PREIS 1.DRUCKFARBE GRAVURLASER-,15 -,33 -,60 -,14 -,30 1.500 -,55 -,13 -,25 -,49 -,12 -,20 10.000 -,39 -,10 -,17 Druckkosten weitere Farben: siehe Onlineshop
* Komplettpreis inklusiv einfarbigem, einseitigen Werbeaufdruck in Standardschrift WERBETIPP blauWAGEN-CHIPS 3 KAPSELHEBERWAGEN-CHIPMETALL-EINKAUFS-MIT ab 0 89 185WERBEIDEEN | ALLTAGSBEGLEITERSINDDIEBESTENWERBETRÄGER 1 „IN-HOUSE“METALL-SCHLÜSSELANHÄNGER Als kleine Aufmerksamkeit zum Einzug oder passend zu Ihrer Branche, etwa im Bau- oder Immobiliengewerbe – der hochglänzende Edelstahl-Schlüsselanhänger in Hausform ist in jedem Fall ein originelles Präsent. Maße: 5 x 3,8 cm L Lasergravur. Fläche: 25 x 10 mm Preis/Stk.: ab 100 Stück -,45 Werkzeugkosten: Siehe Serviceseiten. 158 324 ab -,99 STÜCKAB STÜCK-PREIS GRAVURLASER1 1,45 100 1,30 -,45 250 1,20 -,35 1.000 1,09 -,32 2.500 -,99 -,28
Schlüsselanhänger aus leichtem Aluminium mit integriertem Kapselheber und Schlüsselring. Maße: ca. 5,5 x 0,8 x 1 cm W Werbedruck. Fläche: auf silbernen Anhänger, ca. 30 x 6 mm, Preis/Stk.: ab 500 Stück -,20 L Lasergravur. Fläche: auf blauen, roten und schwarzen Anhänger, Preis/Stk.: ab 500 Stück -,30 Werkzeugkosten: Siehe Serviceseiten. 274 264 blau ab -,19 160 753 rot ab -,19 160 761 schwarz ab -,19 274 272 silber ab -,19 STÜCKAB STÜCK-PREIS 1.DRUCKFARBE GRAVURLASER1 -,25 500 -,22 -,20 -,30 1.000-,21 -,18 -,28 -,17 -,25 -,15 -,22 Druckkosten weitere Farben: siehe Onlineshop KAPSELHEBERSCHLÜSSELANHÄNGER/„EASY“
5.000-,19
3001-,69-,65
750
4
ab 300
2 HOLZ-SCHLÜSSEL-ANHÄNGER„WOODY“ ab 0 39 1 „IN-HOUSE“ANHÄNGERMETALL-SCHLÜSSELab 0 99
ab 0 19 3 MITMETALL-EINKAUFS-WAGENCHIPKAPSELHEBER Bei diesem Einkaufswagenchip dreht sich was! In seiner Halterung kann sich der Chip drehen. Mit Schlüsselanhänger und Kapselheber. W Werbedruck. Fläche: 20 x 12 mm Preis/Stk.: ab 100 Stück -,42 Werkzeugkosten: Siehe Serviceseiten. 129 878 blau ab -,89 271 287 grün ab -,89 129 894 weiß ab -,89 129 886 rot ab -,89 271 295 gelb ab -,89 STÜCKAB STÜCK-PREIS 1.DRUCKFARBE 1 1,35 100 1,25 -,42 500 1,15 -,38 1.000 1,10 -,35 2.500 -,89 -,30 Druckkosten weitere Farben: siehe Onlineshop
Fläche: 35 x 15 mm
Serviceseiten. 170 056 ab
4 KAPSELHEBERSCHLÜSSELANHÄNGER/„EASY“
2.500-,20















































3 starke LEDs Lieferung nur für den gewerblichen Bedarf. Alle Preise zzgl. MwSt.186 | WERBEIDEEN3„SPOTLED-TASCHENLAMPEIN“ ab 0 49 2 „METALBASIC“LED-TASCHENLAMPE ab 2 45 2 „METALBASIC“LED-TASCHENLAMPE 9 lichtstarke LED s machen die Nacht zum Tag. Passt in jede Tasche oder mit dem kleinen, abnehmbaren Trageriemen auch an den Gürtel. Die LEDTechnik bietet extrem helles Licht. Hinweis: Betrieb über 3 Micro (AAA)Batterien, im Lieferumfang enthalten. Lieferung im Einzelkarton. W Werbedruck. Fläche: Gehäuse: 22 x 8 mm Preis/Stk.: ab 40 Stück -,72 L Laserbeschriftung. Fläc he: Gehäuse: 24 x 8 mm Preis/Stk.: ab 40 Stück -,99 Werkzeugkosten: Siehe Serviceseiten. 099 385 silber ab 2,45 099 393 blau ab 2,45 099 408 rot ab 2,45 099 416 grün ab 2,45 105 636 goldfarben ab 2,45 STÜCKAB STÜCK-PREIS 1.DRUCKFARBE GRAVURLASERDruckkosten5.0001.0005001504013,95–3,65-,72-,993,45-,62-,853,25-,52-,752,95-,42-,652,45-,22-,45weitereFarben:sieheOnlineshop 1 LED-TASCHENLAMPE mit Flaschenöffner Diese formschöne Taschenlampe passt an jeden Schlüsselbund und kann zugleich als Flaschenöffner genutzt werden. Aus mattem Aluminium Maße: Ø 1,5 x 7 cm Hinweis: Batterien sind im Lieferumfang enthalten. W Werbedruck Fläche: 20 x 7 mm Preis/Stk.: ab 60 Stück -,45 Werkzeugkosten: Siehe Serviceseiten. 121 749 schwarz ab 1,69 121 757 rot ab 1,69 121 765 blau ab 1,69 121 773 grün ab 1,69 121 781 silber ab 1,69 STÜCKAB STÜCK-PREIS 1.DRUCKFARBE 6012,192,09 -,45 250 1,99 -,40 500 1,89 -,35 1.000 1,79 -,30 2.500 1,69 -,20 Druckkosten weitere Farben: siehe Onlineshop 1 LED-TASCHENLAMPE MIT FLASCHENÖFFNER ab1 69 3 LED-TASCHENLAMPE „ SPOT IN“ Kleine Lampe mit großer Ausstrahlung! Die LED-Taschenlampe aus Kunststoff im matten Metallic-Look kann dank Schlüsselring an Taschen & Co. griffbereit befestigt werden. Inkl. Batterien. Maße: Ø 1,5 x 8,5 cm W Werbedruck. Fläche: 50 x 9 mm Preis/Stk.: ab 200 Stück -,20 Werkzeugkosten: Siehe Serviceseiten. 190 647 schwarz ab -,49 190 655 blau ab -,49 190 663 rot ab -,49 190 671 silber ab -,49 STÜCKAB STÜCK-PREIS 1.DRUCKFARBE 1 -,75 200 -,70 -,20 500 -,65 -,18 1.000 -,60 -,17 2.500 -,52 -,15 5.000 -,49 -,13 Druckkosten weitere Farben: siehe Onlineshop




































































mit Geschenkbox 50015,953,95 -,60 Druckkosten weitere Farben: siehe Onlineshop 187WERBEIDEEN | 1 LED-TASCHENLAMPE mit Schlüsselkarabiner Klein aber mit enormer Leuchtkraft. Drei LED-Lampen machen diese Taschenlampe mit Schlüsselkarabiner aus Metall besonders leistungsstark. Auffallend schön ist die matte Optik des Metallgehäuses, welches in den Farben Schwarz, Rot, Blau, Grün und Silber erhältlich ist. Maße: 5,5 x Ø 1,5 cm Hinweis: Batterien sind im Lieferumfang enthalten. W Werbedruck Fläche: 15 x 8 mm Preis/Stk.: ab 100 Stück -,48 Werkzeugkosten: Siehe Serviceseiten. 121 693 schwarz ab 1,19 121 708 rot ab 1,19 121 716 blau ab 1,19 121 724 grün ab 1,19 121 732 silber ab 1,19 STÜCKAB STÜCK-PREIS 1.DRUCKFARBE 10011,891,79 -,48 250 1,69 -,44 1.000 1,59 -,38 2.500 1,39 -,32 5.000 1,19 -,28 Druckkosten weitere Farben: siehe Onlineshop 1 LED-TASCHENLAMPE SCHLÜSSELKARABINERMIT ab 1 19 2 „KEYLED-TASCHENLAMPELARGO“ Leuchtende Momente für Ihr Marketing! Die LED-Lampe aus Kunststoff passt an jeden Schlüsselbund und ist zugleich ein perfekter Träger Ihrer Werbebotschaft. Maße: inkl. Schlüsselring 10 x 2,8 x 0,9 cm W Fläche:Werbedruck. 40 x 11 mm Preis/Stk.: ab 250 Stück -,21 Werkzeugkosten: Siehe Serviceseiten. 205 279 schwarz ab -,29 205 287 grün ab -,29 205 295 blau ab -,29 205 300 gelb ab -,29 205 318 rot ab -,29 205 326 silber ab -,29 STÜCKAB STÜCK-PREIS 1.DRUCKFARBE 1 -,49 250 10.000-,292.500-,351.000500-,42-,44-,395.000-,32 -,14 Druckkosten weitere Farben: siehe Onlineshop 2 „KEYLED-TASCHENLAMPELARGO“ ab 0 29 STÜCK STÜCK-PREIS 1.DRUCKFARBE 1 5,95 25 5,75 -,95 50 5,45 -,90 150 4,95 -,85 250 4,45 -,75 500 3,95 -,20-,21-,19-,18-,16 3 LAMPEMETALL-LED„DOME“ ab 3 95 3 METALL-LED LAMPE „DOME“ Enorme Leuchtkraft dank 14 MiniLEDs. Diese Taschenlampe im schwarzen Metallgehäuse bringt garantiert Licht ins Dunkel. Maße: Ø 3 x 12 cm Hinweis: Drei AAA-Batterien sind im Lieferumfang enthalten. W Werbedruck Fläche: 30 x 8 mm Preis/Stk.: ab 25 Stück -,95 Werkzeugkosten: Siehe Serviceseiten. 139 090 ab 3,95




















































Softscheibefaltbare DRUCK4C Durchmesser28cm 200 013buntWURFSCHEIBENgemischt384 219.-WERBETIPP* Lieferung nur für den gewerblichen Bedarf. Alle Preise zzgl. MwSt.188 | WERBEIDEEN 3 WASSERBALL „SPIELSPASS“ Ein Klassiker unter den Werbeartikeln – und das aus gutem Grund. Bedruckt mit Ihrem Firmenlogo erreichen Sie mit diesen zweifarbigen Wasserbällen aus Kunststoff im Nu ein ganzes Freibad. Maße: Ø 28 cm SP Spezialdruck. Fläche: Segment, 150 x 60 Preis/Stk.:mmab 200 Stück -,37 Werkzeugkosten: Siehe Serviceseiten. 123 943 weiß/grün ab -,69 123 951 weiß/orange ab -,69 010 270 weiß/blau ab -,69 010 374 weiß/rot ab -,69 010 655 weiß/gelb ab -,69 1 WURFSCHEIBE FALTBAR Durch Verdrehen zusammenfaltbare Wurfscheibe aus Nylongewebe. Die stabile Form kommt durch einen eingelegten, flexiblen Draht. So hat man in Nullkommanix ein Sportgerät für unterwegs gezaubert. Nach dem Spiel ist die Scheibe im mitgelieferten Täschchen einfach zu verstauen. Maße geöffnet ca. Ø 24 cm. geschlossen: ca. Ø 9,5 cm SP Spezialdruck. Fläche: Wurfscheibe, ca. 170 x 170 mm SP Spezialdruck. Fläche: Etui, ca. 50 x 50 mm Preis/Stk.: ab 200 Stück -,40 Werkzeugkosten: Siehe Serviceseiten. 082 345 blau ab -,33 082 353 rot ab -,33 082 361 gelb ab -,33 2 WURFSCHEIBE Stapelbare Wurfscheibe aus Polypropylen in sommerlichen Farben. Maße: Ø 21,5 cm Hinweis: Nicht für Kinder unter 3 Jahren geeignet. W Werbedruck. Fläche: Ø 80 mm Preis/Stk.: ab 250 Stück -,30 Werkzeugkosten: Siehe Serviceseiten. D Digitaldruck 4c. Fläche: Ø 80 cm Preis/Stk.: ab 250 Stück -,90 Datenhandling: einmalig 29,023 056 rot ab -,49 023 064 weiß ab -,49 023 072 gelb ab -,49 135 146 blau ab -,49 135 154 grün ab -,49 2 WURFSCHEIBE ab 0 49 1 FALTBARWURFSCHEIBE ab 0 33 STÜCKAB STÜCK-PREIS 1.DRUCKFARBE 1 -,60 200 -,55 -,40 1.000 -,49 -,38 2.500 -,45 -,36 5.000 -,39 -,34 10.000 -,33 -,30 Druckkosten weitere Farben: siehe Onlineshop 3 „SPIELSPASS“WASSERBALL ab 0 69 STÜCKAB STÜCK-PREIS 1.DRUCKFARBE DIGITAL4C Druckkosten10.0002.5001.0002501-,75–-,69-,30-,90-,55-,29-,75-,52-,27-,65-,49-,25-,55weitereFarben:sieheOnlineshop STÜCKAB STÜCK-PREIS 1.DRUCKFARBE WEITEREFARBE Druckkosten5.0001.50060020011,19–-,99-,37-,29-,89-,35-,28-,79-,34-,27-,69-,30-,26weitereFarben:sieheOnlineshop

















































































Baut Stress ab und kräftigtdieHände 4 ANTI-STRESS STERN „STARLET“ ab 0 49 4 ANTI-STRESS STERN „STARLET“ Gute Laune statt Stress. Gerade in der Weihnachtszeit geht es manchmal hoch her. Darum empfehlen wir: Einfach einen Stern kneten, quetschen, drücken und nach der Anspannung die Entspannung genießen Maße: Ø 7,5 cm W Werbedruck. Fläche: Ø 3 cm Preis/Stk.: ab 200 Stück -,50 Werkzeugkosten: Siehe Serviceseiten. 188 320 weiß ab -,49 188 338 blau ab -,49 188 346 rot ab -,49 188 354 gelb ab -,49 STÜCKAB STÜCK-PREIS 1.DRUCKFARBE 1 -,89 200 -,79 -,50 500 -,69 -,45 1.000-,65 -,40 5.000-,59 -,35 10.000-,49 -,30 Druckkosten weitere Farben: siehe Onlineshop 189WERBEIDEEN | 1 QUIETSCHE-ENTE GROSS Sympathischen Quietsche-Ente aus Kunststoff. Die große Druckfläche lässt dabei Ihre Werbung gut aussehen. Nicht für Kinder unter 3 Jahre geeignet. Maße: ca. 10 x 9 x 8 cm W Werbedruck. Fläche: 30 x 10 mm Preis/Stk.: ab 100 Stück -,55 Werkzeugkosten: Siehe Serviceseiten. 283 431 ab 1,29 2 GUMMIBÄLLE, 1 SET / 50 STK. Gummibälle mit einem Durchmesser von 5,5 cm. Lieferung erfolgt bunt gemischt in 5 Farben. Nicht für Kinder unter 3 Jahre geeignet. W Werbedruck. Fläche: 35 x 35 mm Preis/Set: ab 4 Sets 10,50 Werkzeugkosten: Siehe Serviceseiten. 035 871 ab 29,95 2 GUMMIBÄLLE ab 29 95 3 INJONGLIERBÄLLEBEUTEL ab 2 35 1 ENTEQUIETSCHE-GROSS ab 1 29 SETAB PREISSET- DRUCK/SET1.FARBE 4141,9540,95 10,50 10 39,95 10,50 35,95 8,150 29,95 7,Druckkosten weitere Farben: siehe Onlineshop STÜCKAB STÜCK-PREIS 1.DRUCKFARBE 10011,951,89 -,55 300 1,79 -,50 1.000 1,59 -,40 2.500 1,39 -,30 5.000 1,29 -,20 Druckkosten weitere Farben: siehe Onlineshop 3 JONGLIERBÄLLE IN BEUTEL Jonglieren macht jedem Spaß und stärkt Konzentration und Gleichgewichtsgefühl. Die drei Jonglierbälle mit ihren witzigen Gesichtern sind in einem Nylonbeutel, der Platz für Ihre Werbebotschaft bietet. Maße: Beutel ca. 15 x 6 x 6 cm. SP Spezialsiebdruck auf Beutel. Fläche: 80 x 40 mm Preis/Stk.: ab 35 Stück -,95 Werkzeugkosten: siehe Serviceseiten. 183 246 ab 2,35 STÜCKAB STÜCK-PREIS 1.DRUCKFARBE 3513,953,75 -,95 100 3,55 -,75 250 3,30 -,65 500 2,95 -,55 1.000 2,75 -,30 3.000 2,35 -,20 Druckkosten weitere Farben: siehe Onlineshop 100 QUIETSCHE- ENTEN 286 055 269.-WERBETIPP* 200 063buntGUMMIBÄLLEgemischt912 229.-WERBETIPP* * Komplettpreis inklusiv einfarbigem, einseitigen Werbeaufdruck in Standardschrift BÄLLE


































































Diese wiederverwendbaren, mit Gel gefüllten Wärmekissen halten Ihre Hände garantiert warm und sind auch bei einem verspannten Nacken wohltuend. Maße: 9,5 x 5,5 x 2 cm W Werbedruck. Fläche: 45 x 20 mm Preis/Stk.: ab 130 Stück -,50 Werkzeugkosten: Siehe Serviceseiten. 158 041 weiß ab -,79 158 050
blau ab -,79 158 068 rot ab -,79 STÜCKAB STÜCK-PREIS 1.DRUCKFARBE 1 1,09 130 -,99 -,50 250 -,95 -,45 1.500-,89 -,40 2.500-,79 -,35 Druckkosten weitere Farben: siehe Onlineshop 3 WÄRMEKISSEN ab 0 79 Lieferung nur für den gewerblichen Bedarf. Alle Preise zzgl. MwSt.190 | WERBEIDEEN 4 JO-JO Aus stabiliem Kunststoffgehäuse. Hinweis: Nicht für Kinder unter 3 Jahren geeignet. Maße: Ø 5,5 cm W Werbedruck. Fläche: 35 x 35 mm Preis/Stk.: ab 400 Stück -,14 Werkzeugkosten: Siehe Serviceseiten. D Digitaldruck 4c. Fläche: 30 x 30 Preis/Stk.:mmab 400 Stück -,35 Datenhandling: einmalig 29,023 177 weiß ab -,19 023 185 blau ab -,19 023 193 rot ab -,19 023 216 gelb ab -,19 STÜCKAB STÜCK-PREIS 1.DRUCKFARBE DIGITAL4C Druckkosten10.0005.0002.5001.0004001-,39––-,35-,14-,35-,32-,13-,30-,29-,12-,25-,24-,11-,22-,19-,10-,20weitereFarben:sieheOnlineshop 1 MAGNET „RAYMOND“DARTSPIEL Einfach ausrollen, aufhängen und schon kann das Spiel beginnen. Auf diese doppelseitig bespielbare Dartscheibe mit deutscher und englischer Ringeinteilung wird mit 6 magnetischen Pfeilen geworfen. Dadurch ist das Spiel auch für Kinder bestens geeignet. Aus stabiler Hartpappe, Polyester und Metall mit Maße:Kunststoffstange.35x45cm 215 697 10,95 1 MAGNET „RAYMOND“DARTSPIEL 10 95 RückseiteLeichtzuverstauen 4 JO-JO ab 0 19 400 062buntJO-JOgemischt326 219.-WERBETIPP* DRUCK4C
2 „FOLKLORE“HOLZ-WINDFÄCHER ab 1 19 STÜCKAB STÜCK-PREIS 1.DRUCKFARBE 1 2,15 70 1,99 -,65 150 1,89 -,60 500 1,79 -,55 1.500 1,59 -,50 2.500 1,39 -,40 5.000 1,19 -,35 Druckkosten weitere Farben: siehe Onlineshop 2 „FOLKLORE“HOLZ-WINDFÄCHER Nutzen Sie eine besonders elegante Art und Weise, um bei Hitze einen kühlenden Luftzug zu genießen. Der Holzgriff des Handfächers bietet zugleich beste Möglichkeiten, erfrischende Werbebotschaften zu platzieren. Maße: 42,5 x 23 cm W Werbedruck. Fläche: 60 x 8 mm Preis/Stk.: ab 70 Stück -,65 Werkzeugkosten: Siehe Serviceseiten. 181 960 weiß ab 1,19 181 978 rot ab 1,19 183 551 royalblau ab 1,19 187 538 schwarz ab 1,19 3 WÄRMEKISSEN


















































































191WERBEIDEEN | 1 SKATSPIEL Skatspiel Klassiker im Klarsichtetui. Perfekt für zu Hause und unterwegs. Maße: 9,5 x 6,5 x 1,5 cm W Werbedruck. Fläche: Etui: 40 x 60 mm Preis/Stk.: ab 100 Stück -,35 Werkzeugkosten: Siehe Serviceseiten. 027 767 ab -,79 1 SKATSPIEL ab 0 79 STÜCKAB STÜCK-PREIS WERBEDRUCK1C 10011,451,15 -,35 250 1,05 -,30 500 -,95 -,28 1.000-,85 -,25 2.000-,79 -,20 STÜCKAB STÜCK-PREIS DRUCK1C DRUCK4C 3502,35 1,60 3,10 5001,75 1,20 2,20 1.0001,15 -,80 1,30 3.000-,69 -,50 -,70 SKATSPIEL MIT INDIVIDUELLEM DRUCK AUF KARTENRÜCKSEITE Maße: 9,5 x 6,5 x 1,5 cm SP Spezialdruck. Fläche: Kartonrückseite, 51 x 82 mm Preis/Stk. 1C: ab 350 Stück 1,60 Preis/Stk. 4C: ab 350 Stück 3,10 Werkzeugkosten: Siehe Serviceseiten. Lieferzeit: ca. 4-6 Wochen. Mehr- oder Minderlieferungen sind bis zu 10% möglich. 179 682 ab -,69 2 REISESPIEL „4 IN EINER REIHE“ Wer schafft es als erstes, vier gleichfarbige Steinchen in einer Reihe zu platzieren? Mit diesem Spieleklassiker im praktischen Taschenformat kommt auf Reisen keine Langweile auf. . Maße: Beutel 14 x 18 x 4 cm SP Spezialsiebdruck. Fläche: auf Beutel 70 x 30 mm Preis/Stk.: ab 60 Stück -,95 Werkzeugkosten: Siehe Serviceseiten 195 634 ab 1,59 STÜCKAB STÜCK-PREIS 1.DRUCKFARBE 6012,592,29 -,95 1502,19 -,80 500 1,95 -,70 1.0001,75 -,60 2.500 1,59 -,40 Druckkosten weitere Farben: siehe Onlineshop 2 REISESPIEL „4 IN EINER REIHE“ ab 1 59 3 MIKADO SPIEL Das Geschicklichkeitsspiel, das schon die alten Römer liebten. Die 41 Stäbchen sind ganz klassisch in einer Holzbox mit Schiebedeckel verpackt, die perfekte Möglichkeiten für Ihre individuelle Werbeanbringung bietet. Maße: 19,5 x 4 x 2,4 cm W Werbedruck. Fläche: 80 x 15 mm Preis/Stk.: ab 150 Stück -,25 Werkzeugkosten: Siehe Serviceseiten. 204 794 ab -,69 STÜCKAB STÜCK-PREIS 1.DRUCKFARBE 15011,191,09 -,25 500 -,99 -,18 1.000 -,89 -,17 2.500 -,79 -,16 5.000 -,69 -,14 Druckkosten weitere Farben: siehe Onlineshop 3 MIKADO SPIEL ab 0 69 * Komplettpreis inklusiv einfarbigem, einseitigen Werbeaufdruck in Standardschrift






































Mit Einlegeblatt Werbeanbringungfür 1 REGENPONCHO ab 0 42 2 REGENSCHIRM „GENF“EINKAUFSTASCHEMIT ab 4 95 Lieferung nur für den gewerblichen Bedarf. Alle Preise zzgl. MwSt.192 | FREIZEIT 1 REGENPONCHO TRANSPARENT Praktischer Poncho in Universalgröße mit Kapuze als idealer Kleidungsschutz. W Fläche:Werbedruck. auf Papiereinleger Preis/Stk.: ab 200 Stück -,35 Werkzeugkosten: siehe Serviceseiten. 187 691 transparent ab -,42 160 657 blau ab -,42 160 665 rot ab -,42 160 673 gelb ab -,42 STÜCKAB STÜCK-PREIS 1.DRUCKFARBE 1 -,69 200 -,59 -,35 1.000 -,56 -,32 2.000 -,53 -,30 5.000 -,48 -,28 10.000 -,42 -,25 Druckkosten weitere Farben: siehe Onlineshop 3 GOLFSCHIRM RAINBOW Der großformatige Regenschirm bringt Farbe in trübe Regentage und hält dank Metallstock und -speichen auch starken Böen stand. Holzgriff und Polyester-Pongee-Bespannung, Schließband mit Klettverschluss. Maße: Ø 120 cm SP Fläche:Spezialsiebdruck. 150 x 110 mm Preis/Segment: ab 15 Stück 1,95 Werkzeugkosten: siehe Serviceseiten. 220 927 ab 5,95 3 GOLFSCHIRMRAINBOW ab 5 95 STÜCKAB STÜCK-PREIS 1.DRUCKFARBE 1 9,45 15 9,15 1,95 50 8,75 1,60 100 7,95 1,30 250 6,95 1,800 5,95 -,95 Druckkosten weitere Farben: siehe Onlineshop 2 REGENSCHIRM MIT EINKAUFSTASCHE „GENF“ Handlicher Taschenschirm, der bei Bedarf groß rauskommt. Schaft und Gestell sind aus Metall, die Bespannung aus Pongee (190T). Besonders praktisch: Das Etui lässt sich zu einer geräumigen Einkaufstasche entfalten. Maße: Ø 97 cm SP Fläche:Spezialsiebdruck. 120 x 190 mm auf die Tasche, oder 200 x 100 mm auf ein Schirm-Segment Preis/Stk.: ab 15 Stück 2,95 Werkzeugkosten: Siehe Serviceseiten. 205 182 blau ab 4,95 205 199 rot ab 4,95 205 203 grün ab 4,95 205 211 schwarz ab 4,95 STÜCKAB STÜCK-PREIS DRUCK 1. FARBE AUF TASCHE DRUCK 1. FARBE AUF SCHIRM 1518,257,95 2,95 2,95 407,45 2,50 2,50 100 6,95 2,20 2,20 2506,45 1,85 1,85 500 5,95 1,65 1,65 1.0004,95 1,20 1,20 Druckkosten weitere Farben: siehe Onlineshop





























































INFINDETJEDERTASCHEPLATZ 36 040STOCKSCHIRMEREGENBOGEN-725 259.-WERBETIPP* * Komplettpreis inklusiv einfarbigem, einseitigen Werbeaufdruck in Standardschrift praktischerTragegriff 30 185TASCHENSCHIRME042blau 195.-WERBETIPP* 193FREIZEIT | 2 „LIMBO“STOCKSCHIRM Metallstock und -speichen, farblich abgestimmte Kunststofftips, Griff in Holz-Optik, SchließbandPolyester-Bespannung,mitKlettverschluss Material: Nylon-Bespannung. Maße: Spannweite 103 cm, 84 cm lang. SP Fläche:Spezialsiebdruck. 200 x 110 mm Preis/Segment: ab 30 Stück 1,45 Werkzeugkosten: Siehe Serviceseiten. 186 504 rot ab 2,95 186 512 orange ab 2,95 186 529 weiß ab 2,95 186 537 dunkelblau ab 2,95 186 545 grün ab 2,95 186 002 regenbogen ab 2,95 2 „LIMBO“STOCKSCHIRM ab 2 95 STÜCKAB STÜCK-PREIS 1.DRUCKFARBE 1 4,95 30 4,65 1,45 100 4,45 1,25 250 4,05 1,500 3,60 -,95 800 3,30 -,80 1.500 2,95 -,60 Druckkosten weitere Farben: siehe Onlineshop 1 SCHIRMTASCHENab 2 35 STÜCKAB STÜCK-PREIS 1.DRUCKFARBE 3013,953,65 1,55 100 3,25 1,25 250 3,05 1,10 500 2,65 -,95 1.000 2,35 -,80 Druckkosten weitere Farben: siehe Onlineshop 1 TASCHENSCHIRM Findet in jeder Tasche Platz. Mit silberfarbenem Metallgestänge, gerilltem Kunststoffgriff und praktischer Trageschlaufe. Aus 100% Polyamid. Inkl. Schutzhülle. Maße: Spannweite 78 cm, in der Schutzhülle nur 32 cm kurz SP Fläche:Spezialsiebdruck. 160 x 140 mm Preis/Segment: ab 30 Stück 1,55 Werkzeugkosten: Siehe Serviceseiten. 077 397 blau ab 2,35 077 410 rot ab 2,35 077 436 blau/weiß ab 2,35 077 452 grün/weiß ab 2,35 177 363 schwarz ab 2,35 177 371 weiß ab 2,35 177 380 bunt ab 2,35













































waterSAVE® Bezugsmaterial STÜCKAB STÜCK-PREIS 1 34,25 5 33,75 20 33,25 100 29,95 200 25,95 Druckkosten weitere Farben: siehe Onlineshop 2 KNIRPS DUOMATICTASCHENSCHIRM Setzen Sie auf ein echtes Qualitätsprodukt. Der Taschenschirm von Knirps öffnet sich in Sekundenschnelle per Knopfdruck und hält auch starken Böen sicher stand. Nach Gebrauch verschwindet der leichte Schirm wieder in seiner Hülle und passt in jede Handtasche. Mit Auf-/Zu-Automatik. Maße: Ø 96 x 29 cm (geöffnet) SP Fläche:Spezialsiebdruck. 200 x 100 mm Preis/Segment: ab 5 Stück Werkzeugkosten: Siehe Serviceseiten. 177 517 schwarz 177 525 blau 177 533 rot 177 541 dunkelgrau 177 550 dunkelgrün 1.DRUCKFARBE 2,502,953,955,95 5,95 ab 25,95 ab 25,95 ab 25,95 ab 25,95 ab 25,95 blau rot dunkelgrau dunkelgrün schwarz 2 KNIRPS DUOMATICTASCHENSCHIRM ab 25 95 Lieferung nur für den gewerblichen Bedarf. Alle Preise zzgl. MwSt.194 | FREIZEIT 1 FARE®-STYLE TASCHENSCHIRMMINI-AUTOMATIK-AOC Der FARE-AOC Mini-Taschenschirm besticht durch seine einheitliche Farbgebung. Auch dieses Modell ist mit dem FARE-Windproof-Syste ausgestattet. Weitere Merkmale sind der Soft-Touch-Griff mit silberner Auslösetaste, die elastische Tragekordel sowie das Futteral mit schwarzer Paspelierung. Das Polyester-Pongee Bezugsmaterial aus recycelten Kunststoffen ist STANDARD 100 by OEKO-TEX® zertifiziert und dank original waterSAVE® Bezugsmaterial besonders umweltfreundlich. Maße: Ø 97 x 28,5 cm Gewicht: 350 g Highlights: Automatik, Windproof-System, farbiges Gestänge, Soft-Touch Griff. SP Spezialsiebdruck. Fläche: 210 x 120 mm Preis/Segment: ab 12 Stück 2,50 Werkzeugkosten: siehe Serviceseiten. 158 496 schwarz ab 9,95 158 507 marine ab 9,95 158 515 limette ab 9,95 158 523 petrol ab 9,95 158 531 rot ab 9,95 186 205 grau ab 9,95 STÜCKAB STÜCK-PREIS 1.DRUCKFARBE 1 14,95 12 12,75 2,50 48 12,45 1,95 120 11,95 1,60 200 10,95 1,45 400 9,95 1,25 Druckkosten weitere Farben: siehe Onlineshop 1 FARE®-STYLE SCHIRMAUTOMATIK-TASCHEN-MINI-AOC ab 9 95









































































































Clevere vieleSchliessungÖffnung/fürSituationenIdeal für Taschedie 195FREIZEIT | 3 TASCHENSCHIRMAUTOMATISCHER Lassen Sie Ihre Kunden nicht im Regen stehen. Dieser automatische Taschenschirm sorgt auf Knopfdruck dafür, dass Ihre Kunden immer trocken bleiben. Besser können Sie mit Ihrem Firmennamen nicht punkten. Maße: geschlossen Ø 6 x 28 cm, offen Ø 95 x 50 cm SP Fläche:Spezialsiebdruck. ca. 210 x 120 mm Preis/ Segment: ab 20 Stück 1,75 Werkzeugkosten: Siehe Serviceseiten. 150 713 blau ab 4,95 150 721 weiß ab 4,95 150 730 schwarz ab 4,95 150 748 rot ab 4,95 STÜCKAB STÜCK-PREIS 1.DRUCKFARBE 2016,856,45 1,75 50 6,25 1,45 150 5,95 1,30 500 5,75 1,20 1.000 4,95 -,95 Druckkosten weitere Farben: siehe Onlineshop 3 TASCHENSCHIRMAUTOMATISCHER ab 4 95 1 „FLIPPED“STOCKSCHIRM ab 7 95 1 STOCKSCHIRM „FLIPPED“ Jeder kennt das Problem: Beim Aussteigen aus dem Auto lässt sich ein herkömmlicher Schirm nicht aufspannen, ohne dass man dabei schon erste Tropfen abbekommt. Mit diesem Stockschirm bleiben Sie dank umgekehrtem Öffnungs- und Schließmechanismus immer trocken. Weitere Vorteile sind der CShape-Griff für freie Hände beim Tragen sowie der Doppelbezug mit Ventilationsmuster zur Vermeidung von Luftstauf. Mit einem Metallstock, SchließbandPolyester-Pongee-BespannungFiberglasspeichen,undmitKlettverschluss. Maße: Spannweite 109 cm, 80 cm lang SP Spezialsiebdruck. Fläche: 230 x 150 Preis/Segment.:mm ab 12 Stück 2,50 Werkzeugkosten: Siehe Serviceseiten. 188 207 blau ab 7,95 188 215 rot ab 7,95 188 223 hellgrün ab 7,95 188 231 hellgrau ab 7,95 STÜCKAB STÜCK-PREIS 1.DRUCKFARBE 12111,9510,75 2,50 36 10,25 1,95 100 9,60 1,75 250 8,95 1,40 500 7,95 -,95 Druckkosten weitere Farben: siehe Onlineshop 2 SUPERFLACHMINI-TASCHENSCHIRM Nie mehr kein Schirm dabei! Denn dieser Mini-Taschenschirm fi ndet sogar Platz in der Mantelinnentasche – ohne aufzutragen. In 3 attraktiven Farben lieferbar. Silberfarbenes Gestänge, Trageschlaufe. Maße: geöffnet ca. Ø 90 cm, geschlossen ca. 22 x 7 x 3 cm SP Fläche:Spezialsiebdruck. 200 x 140 mm Preis/ Segment: ab 20 Stück 1,85 Werkzeugkosten: Siehe Serviceseiten. 283 257 blau ab 4,95 283 273 rot ab 4,95 283 265 schwarz ab 4,95 STÜCKAB STÜCK-PREIS 1.DRUCKFARBE 2017,256,75 1,85 50 6,55 1,70 150 6,25 1,45 500 5,65 1,20 1.000 4,95 -,95 Druckkosten weitere Farben: siehe Onlineshop 2 TASCHENSCHIRMMINIab 4 95








































































































sturmfest Windproof-systemSTURMSICHER 2 STOCKSCHIRM FIBERGLAS Ultraleichter Stockschirm in hochwertiger Verarbeitung. Moderne Optik: Außenseite in den Farben blau und schwarz, innen modisches Silber. Vorgeformter weicher Schaumstoffgriff für jederzeit sicheren und bequemen Halt. Zusätzliche Metallöse am Griff. Maße: Stocklänge ca. 82 cm. Spannweite 95 cm Material: Stock aus superleichtem Aluminium, Gestänge aus Fiberglas. Erstklassige Bespannung aus 100% Polyamid. SP Spezialsiebdruck. Fläche: 230 x 150 Preis/Segment:mm ab 20 Stück 1,55 Werkzeugkosten: Siehe Serviceseiten. 255 462 blau ab 4,65 255 132 schwarz ab 4,65 STÜCKAB STÜCK-PREIS 1.DRUCKFARBE 1 7,50 20 6,95 1,55 50 6,75 1,50 100 6,25 1,45 250 5,95 1,25 500 5,25 -,95 800 4,65 -,85 Druckkosten weitere Farben: siehe Onlineshop Gummigriff Ultraleicht 2 FIBERGLASSTOCKSCHIRM ab 4 65 Lieferung nur für den gewerblichen Bedarf. Alle Preise zzgl. MwSt.196 | FREIZEIT 1 STURMSCHIRM Bespannung 100% Nylon/Polyamid. Sturmfestes Gestänge. Maße: ca. 95 cm, Spannweite ca. 120 cm. Highlights: sturmfest, extra-stabil SP Fläche:Spezialsiebdruck. 230 x 130 mm Preis/Segment: ab 15 Stück 1,95 Werkzeugkosten: Siehe Serviceseiten. 212 210 dunkelblau ab 5,95 168 115 schwarz ab 5,95 190 124 rot ab 5,95 1 STURMSCHIRM ab 5 95 STÜCKAB STÜCK-PREIS 1.DRUCKFARBE 1518,958,65 1,95 100 8,25 1,50 250 7,65 1,35 500 6,95 1,25 1.000 5,95 -,95 Druckkosten weitere Farben: siehe Onlineshop 3 SCHIRM „SUBWAY“ Ob in leuchtendem Pink oder klassischem Schwarz, in Weiß, Blau, Orange oder Grün - mit diesem Automatikschirm mit soft ummanteltem schwarzen Gummigriff lassen Sie Ihre Kunden nicht im Regen stehen. Maße: Länge ca 100 cm. Spannweite 125 cm SP Spezialsiebdruck. Fläche: 260 x 200 Preis/Segment:mm ab 20 Stück 1,65 Werkzeugkosten: Siehe Serviceseiten. 133 751 blau ab 5,95 133 760 schwarz ab 5,95 133 778 weiß ab 5,95 133 786 grün ab 5,95 133 794 pink ab 5,95 133 809 orange ab 5,95 3 „SUBWAY“SCHIRM ab 5 95 STÜCKAB STÜCK-PREIS 1.DRUCKFARBE 2017,957,85 1,65 100 7,25 1,45 250 6,55 1,25 500 5,95 -,95 Druckkosten weitere Farben: siehe Onlineshop























































































































: Stocklänge ca. 90 cm, Spannweite ca. 95 cm SP Fläche:Spezialsiebdruck. ca. 200 x 130 mm Preis/ Segment: ab 15 Stück 1,95 Werkzeugkosten: Siehe Serviceseiten. 129 843 blau ab 4,95 129 851 schwarz ab 4,95 129 860 grün ab 4,95 STÜCKAB STÜCK-PREIS 1.DRUCKFARBE 1517,957,45 1,95 50 6,95 1,45 150 6,65 1,10 500 5,95 -,95 1.000 4,95 -,90 Druckkosten weitere Farben: siehe Onlineshop 3 „HOLZ“STOCKSCHIRMAUTOMATIKab 4 95
Eleganter und hochwertiger Stockschirm aus robustem Nylon-Gewebe. Nähte f arblich abgesetzt. Gestänge aus schwarz lackiertem Metall. Stock, und Spitze sind aus hochwertigem Holz verarbeitet. Drücker aus goldfarbenem Kunststoff mit schwarzem Knopf. Maße
Druck Farbsegmentauf goldfarbenerHolzgriffundDrücker 25 273SCHIRMESTOCK-147blau 275.-WERBETIPP* * Komplettpreis inklusiv einfarbigem, einseitigen Werbeaufdruck in Standardschrift 2 AUTOMATIK-STOCKSCHIRM Material: Schaft und Spitze aus Metall, stabiler Griff aus farblich angepasstem PVC. Maße: Spannweite: 102 cm. Länge 88 cm SP Fläche:Spezialsiebdruck. 230 x 150 mm Preis/Segment: ab 30 Stück 1,55 Werkzeugkosten: Siehe Serviceseiten. 040 188 blau ab 3,29 040 196 rot ab 3,29 040 207 gelb ab 3,29 2 STOCKSCHIRMAUTOMATIKab 3 29 STÜCKAB STÜCK-PREIS 1.DRUCKFARBE 3014,954,55 1,55 100 4,25 1,35 250 3,95 1,500 3,65 -,95 1.000 3,29 -,90 Druckkosten weitere Farben: siehe Onlineshop 197FREIZEIT | 1 STOCKSCHIRMAUTOMATISCHER ab2 95 1 STOCKSCHIRMAUTOMATISCHER Diese klassischen Stockschirme sorgen auch an dunklen Regentagen für fröhliche Farbakzente. Mit Holzgriff und Automatikfunktion in vier Farbvarianten. Maße: Ø 100 cm x 83 cm Höhe Highlights: mit Automatikfunktion.Holzgriff, SP Fläche:Spezialsiebdruck. 200 x 100 mm Preis/ Segment: ab 30 Stück 1,45 Werkzeugkosten: Siehe Serviceseiten. 177 912 blau/weiß ab 2,95 177 929 rot/weiß ab 2,95 177 937 gelb/weiß ab 2,95 177 945 grün/weiß ab 2,95 STÜCKAB STÜCK-PREIS 1.DRUCKFARBE 3014,954,65 1,45 150 4,45 1,25 500 3,95 1,1.000 3,45 -,90 2.000 2,95 -,80 Druckkosten weitere Farben: siehe Onlineshop 3 „HOLZ“AUTOMATIK-STOCKSCHIRM
Griff


































































































































HÖCHSTE FREUNDLICHEUMWELT-UNDQUALITÄT Stockfarbiger+Gestänge RotBlau Windproof-systemSTURMSICHER PinkBlau STÜCKAB STÜCK-PREIS 1.DRUCKFARBE 1 13,95 12 11,95 2,25 50 11,45 1,95 100 9,95 1,75 250 8,95 1,45 500 7,95 -,95 Druckkosten weitere Farben: siehe Onlineshop Stockfarbiger+Gestänge Windproof-systemSTURMSICHER waterSAVE® waterSAVEBezugsmaterial ® Bezugsmaterial Lieferung nur für den gewerblichen Bedarf. Alle Preise zzgl. MwSt.198 | FREIZEIT 2 FARE®-STYLE AUTOMATIKSCHIRM MIDSIZE WINDPROOF Mit einem Schirm der Marke FARE® setzen Sie auf ein vom TÜV zertifiziertes Qualitätsprodukt, deren Produktion unter einem besonders humanen und umweltbewussten Verhaltenskodex erfolgt. Das Polyester-Pongee Bezugsmaterial aus recycelten Kunststoffen ist STANDARD 100 by OEKO-TEX® zertifiziert und dank original waterSAVE® Bezugsmaterial besonders umweltfreundlich. Optisch sind FARE® -Style-Schirme äußerst ansprechend. Dieser Midsize Stockschirm mit farbigem Stock, farbiges Gestänge und Griffring sowie formschönem SoftTouch-Rundhakengriff mit Doming-Möglichkeit lässt sich dank Automatikfunktion sehr schnell öffnen und trotzt dank Windproof-System starken Böen. Maße: Ø 112 x 89,5 cm Gewicht: 530 g Highlights: Automatik, Windproof-System, farbiges Gestänge, Soft-Touch Griff. SP Spezialsiebdruck. Fläche: 230 x 140 mm Preis/Segment: ab 8 Stück 2,95 Werkzeugkosten: siehe Serviceseiten. 158 461 schwarz/rot ab 12,95 158 470 schwarz/orange ab 12,95 158 488 schwarz/blau ab 12,95 2 FARE®-STYLE AUTOMATIKSCHIRM MIDSIZE WINDPROOF ab 12 95 STÜCKAB STÜCK-PREIS 1.DRUCKFARBE 1 18,95 8 17,95 2,95 50 16,95 1,95 100 14,95 1,75 250 13,95 1,45 500 12,95 -,95 Druckkosten weitere Farben: siehe Onlineshop 1 FARE®-STYLE STOCKSCHIRMACCOLORLINE Komfortable Automatik-Funktion zum schnellen Öffnen, Windproof-Features für höhere GestellFlexibilität und bessere Windsicherheit, flexible Fiberglasschienen, stabiler Stahlstock mit farbiger Kunststoffummantelung, dezente Verzierung des Bezugs durch farbige Nähte, exklusiver Softgriff, Auslösetaste. Das Polyester-Pongee Bezugsmaterial aus recycelten Kunststoffen ist STANDARD 100 by OEKO-TEX® zertifiziert und dank original waterSAVE® Bezugsmaterial besonders umweltfreundlich. Maße: Ø 105 x 84 cm Gewicht: 360 g Highlights: Automatik, Windproof-System, farbiges Gestänge, Soft-Touch Griff. SP Spezialsiebdruck. Fläche: 230 x 140 mm Preis/Segment: ab 12 Stück 2,25 Werkzeugkosten: siehe Serviceseiten. 186 141 schwarz /blau ab 7,95 186 150 schwarz/orange ab 7,95 186 168 schwarz/pink ab 7,95 1 FARE®-STYLE STOCKSCHIRMACCOLORLINE ab 7 95






















rutschfesterSCHWARZBRAUNSANDRückenROT DUNKELGRAU 2 PROPER SCHMUTZFANGMATTETEX Mit seinem hohen, dichten Flor sieht dieser Läufer außergewöhnlich wohnlich im Eingangsbereich bzw. Flur aus und doch handelt es sich hierbei um eine bei 30°C waschbare Schmutzfangmatte. Zudem sorgt ein rutschhemmender Rücken für sicheren Halt. Der Läufer ist in verschiedenen Maßen erhältlich. Rücken Vinyl, Nutzschicht Polyamid, geeignet für Fußbodenheizung. Made in Germany. 60 x 40 cm 9,95 90 x 60 cm 24,95 150 x 90 cm 59,95 180 x 60 cm 49,95 250 x 90 cm 99,95 2 PROPER TEX SCHMUTZFANGMATTE ab 9 95 60 X 40 CM90 X 60 CM150 X 90 CM180 X 60 CM250 X 90 CM ROT 166 935 166 943 166 951 166 960 166 978 SCHWARZ 166 986 166 994 167 001 167 010 167 028 SAND 167 036 167 044 167 052 167 069 167 077 DUNKELGRAU 167 085 167 093 167 108 167 116 167 124 BRAUN 167 132 167 149 167 157 167 165 167 173 199FREIZEIT | Automatikdrücker 1 „TANGO“HOLZSTOCKSCHIRM Klassischer Holzstockschirm mit edlem Detail. Der Automatikverschluss gleicht bei diesem Schirm einem tief schwarzen Smaragd in goldener Metallfassung. Maße: Ø 103 cm Material: RundhakengriffSchließbandPolyesterbespannung,mitKlettverschluss,ausHolz. SP Fläche:Spezialsiebdruck. 200 x 130 mm Preis/ Segment: ab 25 Stück 1,45 SieheWerkzeugkosten:Serviceseiten. 122 022 schwarz ab 3,95 122 039 weiß ab 3,95 122 047 blau ab 3,95 122 055 rot ab 3,95 122 063 orange ab 3,95 1 „TANGO“HOLZSTOCKSCHIRM ab 3 95 STÜCKAB STÜCK-PREIS 1.DRUCKFARBE 2515,455,25 1,45 150 4,95 1,25 400 4,50 1,1.000 3,95 -,90 Druckkosten weitere Farben: s. Onlineshop 3 SCHMUTZFANGMATTE MIT IHREM LOGO Diese Fußmatte ist Schmutz- und Blickfang zugleich. Mit ihrem Firmenlogo wird sie zur perfekten Visitenkarte bereits im Eingangsbereich Ihres Unternehmens. Die Matte gibt es in vier Größen. Sie ist äußerst robust und strapazierfähig, nimmt feinen Schmutz und Nässe auf und ist selbstverständlich waschbar. Wasseraufnahmekapazität: ca. 3-4 l/m². Qualität: 100% High Twist Nylon (HTN), Polyamid 6.6, Rücken 100% Nitrilgummi. Waschbar, Trocknergeeignet bei 60°, EN 135501-1 zertifiziert, Made in Datenhandling:Europe. einmalig 29,Schicken Sie uns Ihr Logo. Sie erhalten einen kostenlosen Designvorschlag. 171 563 60 x 85 cm ab 49,171 571 85 x 115 cm ab 89,171 580 85 x 150 cm ab 119,171 598 115 x 180 cm ab 199,3 MITSCHMUTZFANGMATTEIHREMLOGO ab 49.–STÜCKAB 60 X CM85 85 X CM115 85 X CM150 115 X CM180 1 55,- 99,-129,-219,10 52,- 94,- 125,- 209,25 49,- 91,- 119,- 199,-





























































Lieferung nur für den gewerblichen Bedarf. Alle Preise zzgl. MwSt.200 | FREIZEIT 2 RUCKSACK „FUN“ Dieser Rucksack macht dank seiner Kunstlederdetails nicht nur beim Sport sondern auch beim Stadtspaziergang oder im Berufsalltag eine gute Figur. Die innere Verstärkung sorgt dafür, dass auch Laptops & Co. gut geschützt sind. Mit zierfähigemverstellbarenReißverschlusshauptfach,Tragegurten,ausstrapa-Nylon. Maße: 29, x 45,5 x 9,4 cm SP Spezialsiebdruck. Fläche: 90 x 120 Preis/Stk.:mmab 10 Stück 2,80 Werkzeugkosten: Siehe Serviceseiten. 161 289 grau ab 7,95 161 297 dunkelblau ab 7,95 161 301 rot ab 7,95 2 „FUN“RUCKSACK ab7 95 STÜCKAB STÜCK-PREIS 1.DRUCKFARBE 10111,4510,95 2,80 50 9,95 1,80 150 9,35 1,40 500 7,95 1,20 Druckkosten weitere Farben: siehe Onlineshop 3 RUCKSACK „HIGH-CLASS“ Ideal für Sport und Reisen ist dieser strapazierfähige Rucksack aus 100 % Polyester. Hohen Tragekomfort garantieren Polster an den Schultergurten und im Rückenbereich. Darüber hinaus lassen ein verstärkter Kopfhörer-Kabelausgang,Tragegriff,inneres und äußeres Reißverschlussfach sowie ein Karabinerhaken keine Wünsche offen. Maße: 48 x 32 x 18 cm Highlights: Kopfhörer-Ausgang, bequeme gepolstertre Schultergurte SP Spezialsiebdruck. Fläche: 100 x 50 Preis/Stk.:mm ab 8 Stück 3,90 Werkzeugkosten: Siehe Serviceseiten. 155 580 blau ab 11,95 155 571 schwarz ab 11,95 3 „HIGH-CLASS“RUCKSACK ab11 95 STÜCKAB STÜCK-PREIS 1.DRUCKFARBE 1 17,95 8 16,95 3,90 20 15,95 2,95 75 14,95 2,40 150 13,95 1,80 500 11,95 1,20 Druckkosten weitere Farben: siehe Onlineshop 1 RUCKSACK „TRENDY“ Ein idealer Sport- und Freizeitrucksack aus leichtem Polyester. Neben den seitlichen Netzfächern verfügt der Rucksack über ein vorderes Extrafach mit Reißverschluss und integriertem Kopfhörerausgang. Maße: 28 x 38 x 13 cm Highlights: mit Media-Player-Fach SP Spezialsiebdruck. Fläche: ca. 110 x 90 mm Preis/Stk.: ab 30 Stück 1,60 Werkzeugkosten: Siehe Serviceseiten. 151 187 blau ab 2,95 151 195 rot ab 2,95 151 200 schwarz ab 2,95 151 218 weiß ab 2,95 151 226 grün ab 2,95 STÜCKAB STÜCK-PREIS 1.DRUCKFARBE 3014,253,95 1,60 100 3,65 1,30 250 3,45 1,05 500 3,25 -,95 1.500 2,95 -,75 Druckkosten weitere Farben: siehe Onlineshop 1 „TRENDY“RUCKSACK ab2 95


















































































































































3 TROLLEY REISETASCHE
geräumige Reisetasche aus Polyester erleichtert das Reisen auf ganzer Linie. Mit einem ReißverschlussHauptfach und sieben OrdnungshaltungReißverschluss-Fächernweiterenwirddieunterwegszum Kinderspiel. Dank Leichtlauf-Skaterrollen mit Kantenschutz und gepolstertem Tragegriff lässt sich auch schweres Gepäck leicht transportieren. Mit Gleitschienen für den Treppentransport sowie Bodenfüßen. Maße: ca. 75 x 30,5 x 33 cm SP Spezialsiebdruck. Fläche: Vorderfach: 90 x 60 mm, seitlich: 250 x Preis/Stk.:120mm ab 3 Stück: 8,Werkzeugkosten: Siehe Serviceseiten. 171 016 schwarz ab 34,95 171 024 blau ab 34,95 171 032 rot ab 34,95 3 TROLLEY REISETASCHE ab34 95 STÜCKAB STÜCK-PREIS 1.DRUCKFARBE 1 49,95 3 46,95 8,15 44,95 4,50 50 39,95 3,50 150 36,95 2,95 250 34,95 2,Druckkosten weitere Farben: siehe Onlineshop 2 RUCKSACK „DANNY“ Dieser leichte Rucksack aus extra softem 600D Polyester passt für viele Gelegenheiten. Die Schultergurte und der Rückenbereich sind gepolstert und sorgen so für angenehmen Tragekomfort. Das Hauptfach wird mit einem Reißverschluss geschlossen. Für Ordnung sorgt ein zusätzliches vertikales Reißverschluss-Vorfach. Maße: 24 x 13,5 x 40,5 cm. SP Spezialsiebdruck. Fläche: 70 x 50 Preis/Stk.:mmab 25 Stück 1,65 Werkzeugkosten: Siehe Serviceseiten. 186 432 grün ab 2,95 186 449 blau ab 2,95 186 457 rot ab 2,95 STÜCKAB STÜCK-PREIS 1.DRUCKFARBE 1 4,95 25 4,75 1,65 100 4,45 1,50 250 3,95 1,30 500 3,65 -,95 1.000 3,25 -,75 1.500 2,95 -,60 Druckkosten weitere Farben: siehe Onlineshop 2 „DANNY“RUCKSACK ab 2 95
1 RUCKSACK „JUST“ 300D POLYESTER Dieser Rucksack lässt keine Wünsche offen: 1 horizontales Reißverschluss-Vorfach, 1 vertikales Reißverschluss-Vorfach, 1 Reißverschluss-Hauptfach mit gepolstertem Innenfach für Laptop oder Tablet und Organizer, seitliches Steckfach ergonomischer verstärkter Tragegriff und gepolsterte Schultergurte Maße: 41,5 x 30 x 12 cm SP Spezialsiebdruck. Fläche: 170 x 130 mm unter Reißverschluss Preis/Stk.: ab 10 Stück 3,50 Werkzeugkosten: Siehe Serviceseiten. 207 155 blau ab 9,95 207 147 anthrazit ab 9,95 STÜCKAB STÜCK-PREIS 1.DRUCKFARBE 1 15,45 10 14,45 3,50 3013,95 2,45 80 12,95 1,95 20011,95 1,65 500 9,95 -,95 Druckkosten weitere Farben: siehe Onlineshop 1 RUCKSACK „JUST“ ab 9 95 201FREIZEIT |
Die





































214 713 hellgrau 69,3 EXPLORERSUNNYBAG 69.Mit SolarpanelabnehmbarespraktischenzahlreichenFächernfürmobileGeräteaufladen Lieferung nur für den gewerblichen Bedarf. Alle Preise zzgl. MwSt.202 | FREIZEIT 2 KOFFERRAUM-FALTBOX Endlich Ordnung im Kofferraum! In dieser praktischen Faltbox mit integrierten Tragegriffen können Einkäufe, Sportsachen, Autozubehör und vieles mehr sicher im Kofferraum verstaut werden. Zwei Fächer mit Einlegeböden sowie ein Netzeinsteckfach; dank Klettverschluss am Boden sowie vier MetallBefestigungsösen bester Halt auch bei turbulenten Fahrten. Nach Gebrauch kann die Box platzsparend zusammengefaltet werden. Maße: ca. 51 x 32 x 26 / 32 x 26 x 4 cm SP Spezialsiebdruck. Fläche: 200 x 90 Preis/Stk.:mmab 12 Stück 2,Werkzeugkosten: Siehe Serviceseiten. 171 379 ab 7,95 STÜCKAB STÜCK-PREIS 1.DRUCKFARBE 1 10,95 12 9,95 2,50 9,45 1,80 150 8,95 1,20 500 7,95 -,95 Druckkosten weitere Farben: siehe Onlineshop 70 238TASCHENMULTIFUNKTIONS-381 289.-WERBETIPP* 1 MULTIFUNKTIONS-TASCHE ab 1 95 1 MULTIFUNKTIONSTASCHE Zahlreiche Anwendungsmöglichkeiten: Multi-Funktionstasche aus strapazierfähigem, abwaschbarem Nylon, mit großem Innenfach und Reißverschluss. Maße: 36,5 x 26 cm SP Spezialsiebdruck. Fläche: 250 x 140 mm Preis/Stk.: ab 50 Stück -,80 Werkzeugkosten: Siehe Serviceseiten. 030 408 ab 1,95 STÜCKAB STÜCK-PREIS 1.DRUCKFARBE 1 2,95 50 2,75 -,80 200 2,45 -,70 1.000 2,22 -,65 2.500 1,95 -,60 Druckkosten weitere Farben: siehe Onlineshop
2 KOFFERRAUM-FALTBOX ab 7 95 3 SUNNYBAG EXPLORER
Dieser vielseitige, funktionale Rucksack ist das Chamäleon unter den Solarrucksäcken. Neben unzähligen praktischen Fächern verfügt der Sunnybag EXPLORER+ auch über ein Solarpaneel, das sich ganz leicht vom Rucksack abnehmen lässt. Somit passt sich der EXPLORER+ jeder Lebenslage an und Rucksack und Paneel können ganz nach Lust und Laune zusammen oder getrennt verwenden. Bei vollem Sonnenschein werden Smartphones je nach Modell in 3-4 Stunden aufgeladen. Größere Geräte wie Drohnen oder Tablets brauchen 6-8 Stunden. Material: Robustes Polyester Textil Maße: 29 x37 x 14 cm




































4
2 ORIGINAL BOTTLEBAGREISENTHELSIGNATURE RED Kein Klappern, kein Klirren. In der Bottlebag mit zwei reißfesten Trageriemen haben bis zu neun 1,5-Liter-Flaschen ihr eigenes stoßgeschütztes Fach. Besonders praktisch: Das Bodenmaß ist auf handelsübliche Fahrradkörbe abgestimmt. So können Getränke auch komfortabel zu Partys und Events mitgenommen werden. Im neuen signature red Design. Material: 100 % Polyester. Maße: 24 x 24 x 28 cm 215 656
Passt in Handtaschejede * Komplettpreis inklusiv einfarbigem, einseitigen Werbeaufdruck in Standardschrift 203FREIZEIT |
Material:
15,95
Polyester. Maße: 48 x 29 x 28 cm 215 672 34,95 1 ORIGINAL REISENTHEL MINI MAXI SHOPPER Winzig klein und bei Bedarf ganz groß. Der
Tragehenkel kann der Shopper auch ganz lässig über
mit
Maxi Shopper
Ein flexibles Band fi xiert die Tasche im
3
flach
ORIGINAL REISENTHEL EASYSHOPPINGBAG SIGNATURE RED Lässt sich auf beiden Seiten über den Einkaufswagen einhängen und befüllen. Das Volumenwunder ersetzt mindestens drei Plastiktüten. Und das bei jedem Einkauf. Nach Gebrauch wird die Tasche aus hochwertigem, wasserabweisenden Polyestergewebe mit zwei stabile Einhängestangen einfach zusammengerollt und der Extrahülle verstaut. Mit Griffpolstern an den Trageriemen und Reißverschluss-Innentasche mit 2 Einkaufswagen-Chips. Material: 100 % Polyester. Maße: 32,5 x 38 x 51 cm 215 664
ORIGINAL CARRYBAGREISENTHELSIGNATURE RED Ein echter Klassiker von reisenthel! Der Einkaufskorb – jetzt im neuen signature red Design – hat einen stabilen Aluminiumrahmen, eine Innentasche mit Reißverschluss sowie einen festen Boden mit Standfüßen. Der Tragegriff ist weich ummantelt und lässt sich umklappen. Das wasserabweisende Gewebe ist aus recycelten PET-Flaschen. Und in den seltenen Fällen, in denen der Korb nicht gebraucht wird, lässt er sich und platzsparend zusammenlegen. 100 % Mini zählt zu den Topstars von reisenthel und ist nun in einer neuen, optimierten erhältlich. zusammengelegten Zustand, den extralangen der Schulter
Version
getragen werden. Aus hochwertigem, wasserabweisenden Poyestergewebe. Material: 100 % Polyester. Maße: 43 x 63 x 6 cm 215 689 4,95 2 ORIGINAL BOTTLEBAGREISENTHELSIGNATURE RED 9 95 4 ORIGINAL SIGNATUREEASYSHOPPINGBAGREISENTHELRED 15 95 3 ORIGINAL SIGNATURECARRYBAGREISENTHELRED 34 95 1 ORIGINAL REISENTHEL MINI MAXI SHOPPER 4 95
9,95






praktischeEinteilung Material aus stabiler LKW-Plane Gefaltet nur 6 cm hoch Lieferung nur für den gewerblichen Bedarf. Alle Preise zzgl. MwSt.204 | FREIZEIT STÜCKAB STÜCK-PREIS 1.DRUCKFARBE 1 20,95 6 19,95 4,95 20 18,95 2,95 100 15,95 2,45 250 13,95 1,95 500 11,95 1,45 Druckkosten weitere Farben: siehe Onlineshop 2 SHOPPER BASKET Praktischer und schöner Einkaufskorb mit Alurahmen und Reißverschluß-Vortasche. Flach zusammenfaltbar. Der leichte Alurahmen verhilft dem Korb zu großer Stabilität auch bei schwerem Inhalt. Stabiles Polyester-Gewebe. Haltegriff mit Klettverschluss. Verstärkter Boden mit Kunststoffnoppen für sicheren Halt. Maße: gefaltet ca. 44 x 28 x 6 cm geöffnet ca. 44 x 28 x 42 cm Highlights: einfach zusammenklappbar SP Fläche:Spezialsiebdruck. 150 x 100 mm Preis/Stk.: ab 6 Stück 4,95 Werkzeugkosten: Siehe Serviceseiten. 084 556 schwarz ab 11,95 084 564 marine ab 11,95 140 041 rot ab 11,95 1 LORRYBAG® ECO Die Original LorryBag ® wird aus stabiler, widerstandsfähiger LKW-Plane gefertigt und bietet eine extra große Werbefläche für Ihr Firmenlogo. Die Inneneinteilung ist praktisch mit einem großen Hauptfach mit Organizer-Elementen sowie einem flachen Einsteckfach. Die Tasche verfügt über einen bequemen Schultergurt (50 mm breit), verstellbar. Die Überschlagsklappe bietet einen praktischen Klettverschluss. Maße: geschlossen ca. 29 x 37 x 13 cm SP Spezialsiebdruck. Fläche: auf Überschlag, ca. 200 x 200 mm Preis/Stk.: ab 10 Stück 2,50 Werkzeugkosten: Siehe Serviceseiten. 094 453 weiß ab 8,95 094 461 schwarz ab 8,95 094 470 royalblau ab 8,95 094 488 rot ab 8,95 1 LORRYBAG ® ECO ab8 952SHOPPER BASKET ab11 95 STÜCKAB STÜCK-PREIS 1.DRUCKFARBE 1 11,95 10 11,50 2,50 50 10,50 1,95 100 9,95 1,20 250 8,95 -,95 Druckkosten weitere Farben: siehe Onlineshop 3 HALFAR RUCKSACK „SPLASH“ Erfrischend geräumig. Für alle, die den Minimalismus des Seesacks lieben, aber den Tragekomfort eines Rucksacks vorziehen, wurde der Rucksack SPLASH entworfen. Mit seinem satten Packvolumen hält er locker eine ganze Tagesausrüstung trocken und sauber. Denn dank seiner LKW Plane mit geschweißten Nähten und dem klassischen Rollverschluss trotzt der Rucksack Wind und Wetter sowie Staub und Schmutz. Maße: 70 x 32,5 x 21,5 cm, 30 Liter SP Spezialsiebdruck. Fläche: 250 x 250 mm Preis/Stk.: ab 6 Stück 4,95 Werkzeugkosten: Siehe Serviceseiten. 214 238 rot ab 13,95 214 246 weiß ab 13,95 214 254 blau ab 13,95 214 262 schwarz ab 13,95 STÜCKAB STÜCKPREIS 1.DRUCKFARBE 1 22,95 6 20,95 4,95 15 19,95 3,45 30 18,95 2,95 100 17,95 2,45 250 15,95 1,95 500 13,95 1,45 Druckkosten weitere Farben: siehe Onlineshop MitClipverschlusspraktischem 3 HALFAR „SPLASH“RUCKSACK ab 13 95























































































































NACHHALTIGE ALTERNATIVEN HOCHWERTIGEN MATERIALIEN ROBUST UND SCHÖN 205FREIZEIT | 1 FILZSHOPPER BASKET Filz in vorbildlicher Formensprache. Ein Augenschmaus war der Shopper schon immer, jetzt wird er außerdem zum Handschmeichler. Der angenehme Filz verleiht der geradlinigen, praktischen Form des Einkaufskorbes eine schöne warme Ausstrahlung. Getreu dem Motto - gebürstetes Aluminium trifft auf geschmeidiges Trendmaterial - setzt der Filzshopper so vielleicht sogar Zeichen für eine neue Einkaufskultur, das Wohlfühlshoppen. Maße: 25 x 45 x 25 cm SP Spezialsiebdruck. Fläche: 150 x 100 mm Preis/Stk.: ab 6 Stück 4,95 Werkzeugkosten: Siehe Serviceseiten. 214 279 ab 11,95 3 PAPIERTASCHE KÜHLFUNKTIONMIT
Laminierte Einkaufstasche aus Papier. Dank einer Folienbeschichtung im Inneren hat diese gleichzeitig
eine Kühlfunktion. Die Tasche besitzt ein Hauptfach mit Reißverschluss sowie eine kleine Tasche an der Seite. Maße: 44 x 14 x 33 cm SP Spezialsiebdruck. Fläche: 110 x 110 Preis/Stk.:mmab 35 Stück 1,10 Werkzeugkosten: Siehe Serviceseiten. 214 422 ab 2,45 STÜCKAB STÜCKPREIS 1.DRUCKFARBE 1 20,95 6 19,95 4,95 15 18,95 3,45 30 17,95 2,95 100 15,95 2,45 250 13,95 1,95 500 11,95 1,45 Druckkosten weitere Farben: siehe Onlineshop STÜCKAB STÜCKPREIS 1.DRUCKFARBE 1 3,65 35 3,25 1,10 100 3,15 -,95 200 3,05 -,85 400 2,85 -,75 1.000 2,65 -,65 2.000 2,45 -,55 Druckkosten weitere Farben: siehe Onlineshop 1 FILZSHOPPER BASKET ab 11 95 3 PAPIERTASCHE KÜHLFUNKTIONMIT ab 2 45 MitKühlfunktion 2 KÜHLTASCHE AUS POLYESTER 600D & KORK Kühltasche aus Polyester (600D) mit Reißverschluss und einem Boden aus Kork. Das Innenmaterial ist thermoregulierend. Die Tasche fasst sechs Dosen mit 0,5 Litern Inhalt. Maße: 25 x 18 x 19 cm SP Spezialsiebdruck. Fläche: auf Deckel 140 x 100 mm Preis/Stk.: ab 30 Stück 1,50 Werkzeugkosten: Siehe Serviceseiten. 221 411 schwarz ab 2,95 221 420 grün ab 2,95 221 438 blau ab 2,95 STÜCKAB STÜCK-PREIS 1.DRUCKFARBE 1 4,95 30 4,45 1,50 60 4,25 1,20 150 3,95 -,95 250 3,75 -,75 500 3,45 -,65 1.000 2,95 -,45 Druckkosten weitere Farben: siehe Onlineshop 2 KÜHLTASCHE AUS POLYESTER 600D & KORK ab 2 95







































80
5.000
in der Dunkelheit nicht übersehen wird. Mit seinen zwei Tragekordeln lässt er sich sowohl als Rucksack als auch über die Schulter tragen. Maße: 44 x 34 cm SP Fläche:Spezialsiebdruck. 220 x 150 mm Preis/Stk.: ab 50 Stück -,95 Werkzeugkosten: Siehe Serviceseiten. 200 049 schwarz ab -,99 200 057 blau ab -,99 200 065 grün ab -,99 200 073 rot ab -,99 200 081 orange ab -,99 STÜCKAB STÜCK-PREIS 1.DRUCKFARBE 1 1,69 50 1,59 -,95 1001,39 -,85 250 1,29 -,75 5001,19 -,65 1.000 1,09 -,55 2.500-,99 -,45 Druckkosten weitere Farben: siehe Onlineshop 1 „BRILLIANT“TURNBEUTEL ab 0 99
400 1,99
7012,452,19
200
500
Lieferung nur für den gewerblichen Bedarf. 1,89 1,69 -,55 1,59 -,53 1,49 -,50 1.500 1,39 -,45 1,29 -,40 Druckkosten Farben: siehe Onlineshop lyester sorgt dass sein Träger dank refl ektierender Streifen auch
2.500
mitInnenfutterisolierendemInnenfutter „BLADES“ Strapazierfähiger Nylonrucksack mit praktischen Details: In die Reißverschlussvordertasche ist ein Kabelausgang für Kopfhörer integriert. Verschluß mit Kordelzug. Maße: 35 x 44 cm SP Fläche:Spezialsiebdruck. 200 x 150 mm Preis/Stk.: ab 70 Stück -,67 Werkzeugkosten: Siehe Serviceseiten. 180 225 blau ab 1,29 180 233 magenta ab 1,29 180 241 grün ab 1,29 180 250 weiß ab 1,29 180 268 schwarz ab 1,29 STÜCK-PREIS 1.DRUCKFARBE -,67 -,62 1,80 -,55 1,49 -,50 -,45
10.000 1,29
dafür,
KabelausgangfürKopfhörerfürKopfhörer 2 RUCKSACK
Alle Preise zzgl. MwSt.206 | FREIZEIT 3 „GYMBAG“KÜHLTASCHE-RUCKSACK Einfach cool! Dieser Rucksack aus Polyester mit Kordelzugverschluss hat ein isolierendes Innenfutter, so dass Einkäufe, Snacks und Getränke auch unterwegs gut gekühlt bleiben. Maße: 31,7 x 1 x 42,5 cm SP Fläche:Spezialsiebdruck. 220 x 150 mm Preis/Stk.: ab 80 Stück -,55 Werkzeugkosten: Siehe Serviceseiten. 183 471 schwarz ab 1,29 183 480 blau ab 1,29 183 498 rot ab 1,29 183 502 weiß ab 1,29 183 519 grün ab 1,29 3 „GYMBAG“RUCKSACKKÜHLTASCHEab 1 29 STÜCKAB STÜCK-PREIS 1.DRUCKFARBE 1
1 TURNBEUTEL „BRILLIANT“ Dieser praktische Turnbeutel aus Po-
Druckkosten weitere Farben: siehe Onlineshop 2 „BLADES“RUCKSACK ab 1 29
weitere
1.000
STÜCKAB



















































































































































207FREIZEIT | 2 FALTBARE EINKAUFSTASCHENYLONab 1 29 2 FALTBARE EINKAUFSTASCHENYLONPraktisch und immer wieder verwendbar! Einkaufstasche aus Nylon, die in sich zusammengefaltet in jede Handtasche passt und bei Bedarf zum Raumwunder für die Einkäufe wird. Maße: 40 x 50 cm SP Fläche:Spezialsiebdruck. 220 x 200 mm Preis/Stk.: ab 70 Stück -,90 Werkzeugkosten: Siehe Serviceseiten. 177 584 blau ab 1,29 177 592 rot ab 1,29 177 605 weiß ab 1,29 177 613 grün ab 1,29 STÜCKAB STÜCK-PREIS 1.DRUCKFARBE 7011,951,75 -,90 250 1,65 -,85 1.000 1,49 -,80 2.000 1,39 -,75 5.000 1,29 -,60 Druckkosten weitere Farben: siehe Onlineshop 1 EINKAUFSTASCHE „STREETS“ Passt in jede Handtasche oder an den Schlüsselbund. Bei Bedarf einfach aus dem dazugehörigen Nylonetui mit Karabinerhaken nehmen. Material: Polyester. Maße: Nylonetui 11,5 x 6 x 2,5 cm. Tasche ca. 43 x 53 cm Highlights: praktisches Etui mit Haken SP Fläche:Spezialsiebdruck. Etui: 60 x 35 mm Preis/Stk.: ab 100 Stück -,70 Werkzeugkosten: Siehe Serviceseiten. 133 237 blau ab -,89 133 245 rot ab -,89 133 253 weiß ab -,89 183 414 gelb ab -,89 183 422 orange ab -,89 STÜCKAB STÜCK-PREIS 1.DRUCKFARBE 1 1,65 100 1,45 -,70 250 1,35 -,65 500 1,20 -,60 1.000 1,15 -,55 2.500 -,99 -,50 5.000 -,89 -,45 Druckkosten weitere Farben: siehe Onlineshop 1 „STREETS“EINKAUFSTASCHE ab0 89 viel Platz 3 DOKUMENTEN-TASCHE Praktische, schwarze Dokumententasche mit Tragegriff. Stabiles NylonGewebe. Farblich abgesetztes Band auf der Vorderseite. Zwei Reißverschlussfächer bieten viel Platz für ihre Unterlagen (bis A4-Format). Maße: 38 x 31 cm Highlights: 2 Reißverschlußfächer, Tragegriff, Zipper SP Spezialsiebdruck. Fläche: 280 x 100 mm Preis/Stk.: ab 50 Stück -,85 Werkzeugkosten: Siehe Serviceseiten. 098 690 blau ab 1,69 098 704 rot ab 1,69 098 831 gelb ab 1,69 098 840 orange ab 1,69 098 858 hellgrün ab 1,69 3 DOKUMENTEN-TASCHE ab1 69 STÜCKAB STÜCK-PREIS 1.DRUCKFARBE 1 2,85 50 2,60 -,85 150 2,40 -,80 500 2,20 -,75 1.000 1,95 -,70 2.500 1,69 -,65 Druckkosten weitere Farben: siehe Onlineshop































































































































3 NON WOVEN RUCKSACK Dieser super leichte KordelzugRucksack aus Non Woven bietet beste Voraussetzungen, um mit flotten Sprüchen, Veranstaltungs- und Firmenlogos Aufmerksamkeit zu erregen. Maße: 30 x 40 cm SP Fläche:Spezialsiebdruck. ca. 200 x 200 mm Preis/Stk.: ab 100 Stück -,57 Werkzeugkosten: Siehe Serviceseiten. 150 990 schwarz ab -,69 151 007 blau ab -,69 151 015 rot ab -,69 151 023 grün ab -,69 151 031 weiß ab -,69 STÜCKAB STÜCK-PREIS 1.DRUCKFARBE 1 -,95 100 -,89 -,57 300 -,85 -,55 1.000 -,80 -,52 3.000 -,75 -,50 5.000 -,69 -,47 Druckkosten weitere Farben: siehe Onlineshop 3 NON RUCKSACKWOVEN ab0 69 Lieferung nur für den gewerblichen Bedarf. Alle Preise zzgl. MwSt.208 | FREIZEIT 2 „DEGREE“KÜHLTASCHE ab2 09 STÜCKAB STÜCK-PREIS 1.DRUCKFARBE 1 3,45 40 3,25 -,90 200 3,15 -,80 500 2,95 -,70 1.000 2,75 -,65 2.000 2,45 -,50 5.000 2,09 -,45 Druckkosten weitere Farben: siehe Onlineshop 2 KÜHLTASCHE „DEGREE“ Diese Kühltasche macht nicht nur beim Einkaufen sondern auch beim Picknick eine gute Figur. Gleiches gilt für Ihre Werbebotschaft, die an den Außenseiten perfekt platziert werden kann. Maße: 35,5 x 25 x 38 cm Füllmenge: ca. 7 l SP Spezialsiebdruck. Fläche: 125 x 130 Preis/Stk.:mmab40 Stück -,90 Werkzeugkosten: Siehe Serviceseiten. 162 290 blau ab 2,09 162 304 rot ab 2,09 162 312 grün ab 2,09 162 329 gelb ab 2,09 1 TASCHE „NON WOVEN“ Eine perfekte Alternative zum klassischen Baumwollbeutel. Die Tragetaschen aus Polypropylen sind nicht nur äußerst leicht und dabei sehr robust, sondern zugleich unschlagbar im Preis. Maße: 41,5 x 37 cm SP Fläche:Spezialsiebdruck. 280 x 250 mm Preis/Stk.: ab 150 Stück -,55 Werkzeugkosten: Siehe Serviceseiten. 124 495 blau ab -,59 124 500 rot ab -,59 124 518 schwarz ab -,59 124 526 weiß ab -,59 124 534 grün ab -,59 124 542 gelb ab -,59 STÜCKAB STÜCK-PREIS 1.DRUCKFARBE 1 -,99 150 -,89 -,55 500-,79 -,50 1.000 -,75 -,48 2.500 -,69 -,45 5.000 -,65 -,42 10.000 -,59 -,40 Druckkosten weitere Farben: siehe Onlineshop 1 „NONTASCHEWOVEN“ ab0 59


































































































































































209FREIZEIT | 3 NON-WOVEN TASCHE „KUFSTEIN“ Diese klassische Non Woven Tasche ist mit ihrer 10 cm Dehnfalte besonders geräumig. Ausführung und in drei Farbvarianten, passend zu Ihrem Werbeaufdruck, erhältlich. Maße: 38 x 29 x 10 cm Highlights: 10 cm breite Dehnfalte SP Spezialsiebdruck. Fläche: 280 x 120 mm Preis/Stk.: ab 120 Stück -,80 Werkzeugkosten: Siehe Serviceseiten. 164 175 blau ab -,69 164 191 gelb ab -,69 164 214 orange ab -,69 3 NON TASCHEWOVEN„KUFSTEIN“ ab0 69 STÜCKAB STÜCK-PREIS 1.DRUCKFARBE 12011,05-,95 -,80 500-,87 -,75 1.000-,79 -,70 5.000 -,75 -,65 10.000 -,69 -,60 Druckkosten weitere Farben: siehe Onlineshop 2 TASCHE „BERN“ NON WOVEN Praktische Einkaufstasche für preisbewusste Einkäufer und damit eine tolle Alternative zur klassischen Baumwolltasche. „Non-Woven“ heißt das Geheimnis – ein extrem robustes, leichtes und langlebiges Material aus Polypropylen. Maße: 38 x 40 cm. Bodenfalte 16 cm SP Spezialsiebdruck. Fläche: 280 x 280 mm Preis/Stk.: ab 120 Stück -,70 Werkzeugkosten: Siehe Serviceseiten. 140 880 blau ab -,75 140 898 rot ab -,75 140 902 schwarz ab -,75 140 919 grün ab -,75 2 TASCHE „BERN“ NON WOVEN ab 0 75 STÜCKAB STÜCK-PREIS 1.DRUCKFARBE 1 1,25 120 1,15 -,70 250 1,05 -,65 500 -,95 -,60 1.500 -,85 -,55 2.500 -,75 -,50 Druckkosten weitere Farben: siehe Onlineshop 1 NON-WOVEN TASCHE „ST. GALLEN“ Wunderbar leichte Tasche aus NonWoven, in der Ihre Kunden auch schwere Unterlagen & Broschüren elegant nach Hause tragen können und dabei Ihre Werbebotschaft immer im Blick haben. Highlights: Mit Dehnfalte, großes Volumen Maße: 38 x 10 x 29 cm SP Spezialsiebdruck. Fläche: ca. 260 x 120 Preis/Stk.:mm ab 150 Stück -,85 Werkzeugkosten: Siehe Serviceseiten. 152 544 blau ab -,65 152 552 rot ab -,65 152 569 orange ab -,65 152 585 gelb ab -,65 STÜCKAB STÜCK-PREIS 1.DRUCKFARBE 15011,151,05 -,85 500 -,95 -,80 1.000 -,85 -,75 3.000 -,75 -,60 5.000 -,65 -,55 Druckkosten weitere Farben: siehe Onlineshop 1 „ST.NON-WOVEN-TASCHEGALLEN“ ab0 65
















































































































Henkeln Lieferung nur für den gewerblichen Bedarf. Alle Preise zzgl. MwSt.210 | FREIZEIT 2 MITBAUMWOLLTASCHEKURZENHENKELN Über dieses Präsent werden sich Ihre Kunden freuen und Ihre Werbung kommt hervorragend zur Geltung: Tasche aus 100% Baumwolle mit zwei Tragehenkeln und großem Fassungsvermögen.Material: 130g/m². Maße: ohne Henkel 42 x 38 cm Highlights: großes Fassungsvermögen SP Fläche:Spezialsiebdruck. 280 x 280 mm Preis/Stk.: ab 100 Stück -,42 Werkzeugkosten: Siehe Service seiten. 032 137 schwarz ab 1,09 032 145 grün ab 1,09 104 215 blau ab 1,09 104 223 rot ab 1,09 104 231 gelb ab 1,09 167 905 weiß ab 1,09 281 962 orange ab 1,09 190 366 grau ab 1,09 100 185185BAUMWOLLTASCHEN026schwarz034blau 245.-WERBETIPP* 2 TASCHEBAUMWOLLab0 99 STÜCKAB STÜCK-PREIS 1.DRUCKFARBE WEITEREFARBE 5.0002.5001.00050010011,85–1,69-,42-,251,55-,36-,231,35-,34-,221,19-,32-,181,09-,31-,16 NACHHALTIGTRAGBARSICHTBAR 1 MITBAUMWOLLTASCHELANGENHENKELN Der klassische Baumwollbeutel – hier in der Variante mit langen Henkeln –ist längst als Fashionaccessoire auf den Laufstegen angekommen und bringt Ihre Werbebotschaft besonders gut zur Geltung. Material: 130g/m². Maße: 42 x 38 cm, ohne Henkel SP Spezialsiebdruck. Fläche: 280 x 280 mm Preis/Stk.: ab 100 Stück -,42 Werkzeugkosten: Siehe Serviceseiten. 154 013 natur ab -,75 154 021 blau ab 1,19 154 030 schwarz ab 1,19 154 048 rot ab 1,19 154 056 grün ab 1,19 154 064 gelb ab 1,19 190 374 grau ab 1,19 1 BAUMWOLLTASCHEMITLANGENHENKELN ab0 75 STÜCKAB NATUR FARBIG 1.DRUCKFARBE WEITEREFARBE 5.0002.5001.00050010011,191,85–1,091,75-,42-,25-,991,59-,36-,23-,951,49-,34-,22-,851,29-,32-,18-,751,19-,31-16 mitHenkelnkurzen


































































































































211FREIZEIT | 3 BAUMWOLLTASCHE Weiß Der Klassiker in weiss aus 100% Baumwolle mit langen Henkeln. Material: 130g/m² Maße: ohne Henkel 42 x 38 cm, Henkel 39 cm lang SP Fläche:Spezialsiebdruck. 280 x 280 mm Preis/Stk.: ab 100 Stück -,42 Werkzeugkosten: Siehe Serviceseiten. 032 024 ab 1,19 2 EINKAUFSTASCHE Einkaufstasche aus naturfarbener Baumwolle. Großes Fassungsvermögen. Große, wirksame Werbefläche. Material: 135g/m² Maße: ohne Henkel 42 x 38 cm SP Spezialsiebdruck. Fläche: 280 x 280 mm Preis/Stk.: ab 120 Stück -,42 Werkzeugkosten: Siehe Serviceseiten. 032 065 natur ab -,75 STÜCKAB STÜCK-PREIS 1.DRUCKFARBE WEITEREFARBE 1 1,29 120 1,15 -,42 -,25 250 -,99 -,37 -,24 500 -,95 -,36 -,23 1.000 -,89 -,34 -,22 2.500 -,79 -,32 -,18 5.000 -,75 -,31 -16 STÜCKAB STÜCK-PREIS 1.DRUCKFARBE WEITEREFARBE 1 1,89 100 1,75 -,42 -,25 250 1,65 -,37 -,24 500 1,55 -,36 -,23 1.000 1,45 -,34 -,22 2.500 1,25 -,32 -,18 5.000 1,19 -,31 -16 150 TASCHENEINKAUFS-205527natur 275.-WERBETIPP* 100 062TASCHENBAUMWOLL-586weiß 255.-WERBETIPP* 3 TRAGEGRIFFENMITBAUMWOLLTASCHEEXTRALANGEN ab1 19 2 EINKAUFSTASCHE ab0 75 Tragehenkel2lange 1 BAUMWOLLTASCHE „NEVADA“ Einfache Baumwolltaschen mit besonderem Farbtupfer! Denn den langen Henkel gibt es in fünf kräftigen Farben, die perfekt auf die Bedruckung abgestimmt werden können. Maße: 38,7 x 41,5 cm SP Spezialsiebdruck. Fläche: 280 x 280 mm Preis/Stk.: ab 100 Stück -,42 Werkzeugkosten: siehe Serviceseiten. 161 615 schwarz ab -,99 161 623 blau ab -,99 161 631 rot ab -,99 161 640 grün ab -,99 161 658 gelb ab -,99 1 „NEVADA“BAUMWOLLTASCHE ab0 99 STÜCKAB STÜCK-PREIS 1.DRUCKFARBE WEITEREFARBE 5.0002.5001.00050010011,59–1,39-,42-,251,29-,36-,231,19-,34-,221,09-,32-,18-,99-,31-,16 * Komplettpreis inklusiv einfarbigem, einseitigen Werbeaufdruck in Standardschrift










































































22 x cm26 Lieferung nur für den gewerblichen Bedarf. Alle Preise zzgl. MwSt.212 | FREIZEIT 1 BAUMWOLLRUCKSACK Der Baumwollrucksack mit Kordelzugverschluss hat sich längst zum Trendaccessoire für Modebewusste gemausert. Das gibt Ihnen die Möglichkeit Ihre Werbebotschaft besonders gut zur Geltung zu bringen. Maße: 32,5 x 42,5 cm SP Spezialsiebdruck. Fläche: 200 x 150 mm Preis/Stk.: ab 70 Stück -,75 Werkzeugkosten: siehe Serviceseiten. 161 666 natur ab -,99 161 674 schwarz ab -,99 161 682 blau ab -,99 161 699 rot ab -,99 1 RUCKSACKBAUMWOLLab0 99 STÜCKAB STÜCK-PREIS 1.DRUCKFARBE 7012,151,75 -,75 250 1,55 -,70 500 1,30 -,65 2.500 1,15 -,50 5.000 -,99 -,40 Druckkosten weitere Farben: siehe Onlineshop 2 BAUMWOLLTASCHE „CHICO“ 22 x 26 cm Den Klassiker unter den Tragetaschen gibt es auch im handlichen MiniFormat, in vier Farben mit besten Möglichkeiten der Bedruckung. Maße: 22 x 26 cm SP Spezialsiebdruck. Fläche: 150 x 150 Preis/Stk.:mmab200 Stück -,38 Werkzeugkosten: Siehe Serviceseiten. 181 025 natur ab -,69 181 033 blau ab -,69 181 041 schwarz ab -,69 181 050 rot ab -,69 STÜCKAB STÜCK-PREIS 1.DRUCKFARBE WEITEREFARBE 10.0005.000-,79-,28-,162.000100050020011,09–-,99-,38-,25-,95-,36-,23-,89-,34-,22-,85-,30-,18-,69-,25-,15 2 „CHICO“BAUMWOLLTASCHE ab 0 69





































































































213FREIZEIT | 2 KULTURTASCHE „NIGHT + DAY“ Die leichte Art, unterwegs immer alles im Griff zu haben! Und ein attraktiver Werbeträger für jede Zielgruppe! Die Tasche aus robustem, abwaschbarem Kunststoff mit großem Außenfach und hellgrauem Innenfutter gibt es in den Farben Rot, Blau, Grün & Schwarz. Maße: ca. 28 x 18 x 8,5 cm SP Fläche:Spezialsiebdruck. 150 x 70 mm Preis/Stk.: ab 60 Stück -,82 Werkzeugkosten: Siehe Serviceseiten. 111 835 rot ab 1,59 111 827 blau ab 1,59 111 819 schwarz ab 1,59 111 843 grün ab 1,59 STÜCKAB STÜCK-PREIS 1.DRUCKFARBE 1 2,25 60 2,15 -,82 150 2,05 -,77 500 1,95 -,72 1.000 1,75 -,67 3.000 1,59 -,62 Druckkosten weitere Farben: siehe Onlineshop 2 „NIGHTKULTURTASCHE+DAY“ ab1 59 3 KULTURTASCHE „TUBE“ Diese Kulturtasche hält Kosmetikartikel dank drei Einsteckfächern aus Netz, vier Flakonschlaufen und einem per Druckknopf Randeinestoffstopper.KulturtascheterReißverschlusstäschchenintegrierteminperfek-Ordnung.GeschlossenwirddieperKordelzugmitKunst-Besondersschön:FürbessereÜbersichtkannderobereumgeschlagenwerden. Maße: Ø 16 x 22 cm SP Spezialsiebdruck. Fläche: 150 x 100 mm Preis/Stk: ab 25 Stück 1,50 Werkzeugkosten: Siehe Serviceseiten. 197 433 dunkelblau ab 2,99 197 441 hellblau ab 2,99 197 450 hellpink ab 2,99 STÜCKAB STÜCK-PREIS 1.DRUCKFARBE 1 5,35 25 4,85 1,50 50 4,55 1,40 100 4,30 1,30 250 3,95 1,10 500 3,35 -,95 1.000 2,99 -,65 Druckkosten weitere Farben: siehe Onlineshop 3 „TUBE“KULTURTASCHE ab2 99 1 GÄSTETÜCHER SET „HOME HELPER“ Ideal für jedes Gäste-WC: vier besonders weiche, saugstarke und schnelltrocknende Gästehandtücher aus Baumwolle und Polyester, die in einer dekorativen Box aus Naturholz gereicht werden. Maße Holzbox: 14 x 11 x 9,5 cm, Handtuch: 31 x 28 cm W Werbedruck. Fläche: 80 x 40 mm auf die Preis/Stk.:Boxab 15 Stück 1,95 L Lasergravur. Fläche: 80 x 65 mm auf eine Preis/Stk.:Seiteab 15 Stück 4,50 Werkzeugkosten: Siehe Serviceseiten. 204 809 grau ab 4,95 204 817 weiß ab 4,95 204 825 blau ab 4,95 STÜCKAB STÜCK-PREIS 1.DRUCKFARBE GRAVURLASERDruckkosten5002505,60100407,251517,45–7,351,954,501,504,256,95-,953,95-,903,504,95-,802,50weitereFarben:sieheOnlineshop 1 GÄSTETÜCHER SET „HOME HELPER“ ab 4 95




















































1 „CHILLINGKÜHLHANDTUCH ab 1 89 In Wasser tauchen,auswringen,fertig! jedempasstzuLook 3 „BELLY“GÜRTELTASCHE ab1 49 Mit Reflektoren 2 ARMPHONE HANDYHÜLLE Oberarmtasche für Smartphones aus Neopren. Mit transparenter Front und reflektierenden Details. Klettverschluss. Ideal für viele Geräte. Perfekt beim Joggen, Radfahren oder Fitness. Maße: Hülle 12 x 6 cm (für 4,7‘ Handy), Tasche: 18 x 25 cm W Werbedruck. Fläche: seitlich Display 50 x 10 mm Preis/Stk.: ab 50 Stück -,70 Werkzeugkosten: Siehe Serviceseiten. 220 839 blau ab 1,69 STÜCKAB STÜCKPREIS 1.DRUCKFARBE 1 2,75 50 2,45 -,70 100 2,25 -,60 250 2,15 -,50 500 2,05 -,40 1.000 1,95 -,30 2.500 1,69 -,20 2 HANDYHÜLLEARMPHONE ab 1 69 Lieferung nur für den gewerblichen Bedarf. Alle Preise zzgl. MwSt.214 | FREIZEIT 1 KÜHLHANDTUCH „CHILLING“ Absolutes Must-have bei großer Hitze oder wenn’s beim Sport heiß her geht. Einfach etwas Wasser in die Dose hineingeben, gut schütteln und schon entfaltet das Handtuch einen langanhaltenden Kühleffekt. Das Kühlhandtuch aus leichtem Polyester kann dank des im Deckel integrierten Karabinerhakens überall befestigt werden. Maße Handtuch: 79 x 29 cm, Dose: 17 x Ø 6,5 cm W Werbedruck. Fläche: 15 x 45 mm auf die Preis/Stk.:Doseab 50 Stück -,95 Werkzeugkosten: Siehe Serviceseiten. 204 680 grün ab 1,89 204 698 blau ab 1,89 204 702 schwarz ab 1,89 STÜCKAB STÜCK-PREIS 1.DRUCKFARBE 1 3,10 50 2,85 -,95 1002,55 -,85 250 2,35 -,75 5002,25 -,55 1.000 1,99 -,40 2.0001,89 -,25 Druckkosten weitere Farben: siehe Onlineshop 3 GÜRTELTASCHE „BELLY“ Wir lassen Ihnen freie Hand! Denn Geldbeutel, Mobiltelefon & Co. können ganz einfach in der Gürteltasche verstaut werden, so dass Sie Ihren Aktivitäten ungehindert nachgehen können. Maße: 35,5 x 5,5 x 15 cm SP Fläche:Spezialsiebdruck. 120 x 50 mm Preis/Stk.: ab 60 Stück -,77 Werkzeugkosten: Siehe Serviceseiten. 161 310 schwarz ab 1,49 161 328 blau ab 1,49 161 336 rot ab 1,49 161 344 grün ab 1,49 STÜCKAB STÜCK-PREIS 1.DRUCKFARBE 6012,352,15 -,77 200 1,95 -,72 500 1,85 -,67 1.000 1,65 -,62 2.500 1,49 -,57 Druckkosten weitere Farben: siehe Onlineshop














































































































mit Bordüre SAUGFÄHIGUNDFLAUSCHIGSUPER hochwertigeStickereiaufbreiterBordüreStickereiaufbreiterBordüre hochwertigeStickerei 215FREIZEIT | 1 VOSSENDUSCHTUCH ab 19 95 STÜCKAB HAND-TUCH DUSCH-TUCH STICKEREI 1 11,95 25,95 8 11,45 24,95 4,95 25 10,95 22,95 4,50 100 10,45 21,95 4,10 250 9,95 20,95 3,75 500 8,95 19,95 3,40 1+2 HAND- UND DUSCHTUCH VOSSEN VIENNA STYLE SUPERSOFT Vienna Style aus Supersoft-Garn fühlt sich nicht nur einzigartig fl auschig an, sondern ist vor allem auch super-saugfähig. Das ergibt ein Tuch, welches der Haut schmeichelt und ein wohltuendes Gefühl beim Abtrocknen hinterlässt. Der exklusive Vossen-Stick und die Ton-in-Ton-Stäbchenbordüre charakterisieren diese neuartige Symbiose aus Tradition und Moderne. Qualität: ca. 620 g/m². 100 % Supersoft Baumwolle. ST Stickerei. Fläche: 100 x 30 mm Handtücher Preis/Tuch: ab 8 Stück 4,95 Duschtücher Preis/Tuch: ab 6 Stück 4,95 Einmalige Werkzeugkosten: 55,1 DUSCHTUCH VOSSEN 67 X 140 CM 153 963 rot-rubin ab 19,95 153 971 weiß ab 19,95 153 980 orange fiesta ab 19,95 153 998 grau pepplestone ab 19,95 191 053 deep blue ab 19,95 2 HANDTUCH VOSSEN 50 X 100 CM 153 914 rot rubin ab 8,95 153 922 weiß ab 8,95 153 939 orange fiesta ab 8,95 153 947 grau pepplestone ab 8,95 191 045 deep blue ab 8,95 3+4 HAND- UND DUSCHTUCH „MARI“ Vielfältig einsetzbar, ob im Bad, Hotelzimmer oder im Urlaub, Sauna- und Wellnessbereich. Sie vermitteln immer ein Gefühl des Wohlbefindens. Ein tolles Werbegeschenk, welches Ihre Kunden bei jedem Gebrauch verwöhnen wird. Das Hand-/Duschtuch „Mari“, Qualität: 470 g/m² - ist mit einer breiten Bordüre, die sich perfekt für eine Stickerei eignet, versehen und in 8 Farben erhältlich, jeweils einzeln verpackt im Polybeutel. Material: 100 % Baumwolle 3 DUSCHTUCH, CA. 70 X 140 CM 167 559 weiß ab 8,95 167 567 grau ab 8,95 167 583 bordeaux ab 8,95 167 591 sonnengelb ab 8,95 167 606 grasgrün ab 8,95 167 614 azurblau ab 8,95 167 622 schokobraun ab 8,95 ST Stickerei. Fläche: 100 x 30 mm Preis/Stk.: ab 10 Stück 4,75 Einmalige Werkzeugkosten: 55,4 HANDTUCH, CA. 50 X 100 CM 167 479 weiß ab 3,95 167 487 grau ab 3,95 167 500 bordeaux ab 3,95 167 518 sonnengelb ab 3,95 167 495 apricot ab 3,95 167 526 grasgrün ab 3,95 167 534 azurblau ab 3,95 167 542 schokobraun ab 3,95 ST Stickerei. Fläche: 100 x 30 mm Preis/Stk.: ab 10 Stück 4,75 Einmalige Werkzeugkosten: 55,STÜCKAB HANDTUCHPREIS DUSCHTUCHPREIS STICKEREI 1 5,95 11,45 10 5,75 10,954,75 20 5,45 10,454,50 50 5,25 9,95 4,25 150 4,95 9,45 3,95 500 4,25 9,25 3,40 1.5003,95 8,95 2,95 2 VOSSENHANDTUCH ab 8 95 4 HANDTUCH „MARI“ 50 X 100 CM ab 3 95 3 DUSCHTUCH „MARI“ 70 X 140 CM ab8 95

















































































































GRÖSSE PALE GREY ROT NAVY SCHWARZ S/M 223 267 223 283223 306 223 322 L/XL 223 275 223 291 223 314 223 339 1 FLEXFIT COTTONORGANICCAP ab 9 95 1 FLEXFIT COTTONORGANICCAP Ein Flexfit-Klassiker aus Bio-Baumwolle. Die verstärkte Front des 6-Panel-Caps und der runde Schirm mit seinen acht Ziernähten perfektionieren den sportlichen Look. Die patentierte Flexfit-Technologie (durchgehendes Flexband mit voll geschlossener Rückseite) sichert den perfekten Tragekomfort in jeder Situation. Material: 98% Baumwolle, 2% Elastan SP Spezialsiebdruck. Fläche: Vorne: 90 x 50 mm Preis/Stk.: ab 8 Stück 3,95 Werkzeugkosten: Siehe Serviceseiten. ST Stickerei. Fläche: Vorne, 50 x 50 mm Preis/Stk.: ab 8 Stück 4,95 Werkzeugkosten: einmalig 55,STÜCKAB STÜCKPREIS 1.DRUCKFARBE STICKEREI 1 14,95 8 14,45 3,95 4,95 2013,95 2,45 4,50 5013,45 1,75 4,25 10012,95 1,45 4,10 20011,95 -,95 3,75 5009,95 -,75 3,40 Druckkosten weitere Farben: siehe Onlineshop 2 MÜTZE „BEANIE“ Ob mit Ihrem Firmenlogo bestickt oder neutraldiese eng anliegenden und doppelt gestrickten Strickmützen von Myrtle Beach halten in jedem Fall angenehm warm. Ohne Umschlag. 100% Polyacryl. Gewicht ca. 45 g. Handwäsche. Maße: Unisex ST Stickerei. Fläche: 80 x 50 mm, 1-4 farbig Preis/Stk.: ab 50 Stück 1,95 Einmalige Werkzeugkosten: 55,188 387 schwarz ab 1,79 188 395 hellgrau ab 1,79 188 400 rot ab 1,79 188 418 royalblau ab 1,79 AB STÜCK STÜCKPREIS STICKEREI 1 2,75 50 2,50 1,95 150 2,35 1,85 500 2,15 1,70 1.000 2,05 1,50 2.500 1,95 1,30 5.000 1,79 -,95 2 „BEANIE“MÜTZE ab 1 79 Lieferung nur für den gewerblichen Bedarf. Alle Preise zzgl. MwSt.216 | FREIZEIT







































































































































Der Spitzenplatz für Ihre Werbung. Sportliche Baseballkappe, Schild mit
Pappe verstärkt, eingearbeitetes Schweißband. Einheitsgröße, am Hinterkopf verstellbar. 100% Baumwolle. SP Spezialsiebdruck. Fläche: 90 x 50 mm Preis/Stk.: ab 80 Stück -,55 Werkzeugkosten: Siehe Serviceseiten. ST Stickerei. Fläche: auf Mütze, 1-4 farbig, 50 x 50 mm Preis/Stk.: ab 80 Stück 4,35 Werkzeugkosten einmalig 55,138 056 weiß ab -,89 138 064 blau ab -,89 138 072 schwarz ab -,89 138 089 rot ab -,89 2 BASEBALLKAPPE ab0 89 1 SANDWICH-CAP ab1 39 STÜCKAB STÜCK-PREIS 1.DRUCKFARBE STICK-EREI Druckkosten1.0005002508011,49–1,29-,554,351,19-,503,75-,95-,403,40-,89-,302,95weitereFarben:sieheOnlineshop STÜCKAB STÜCK-PREIS 1.DRUCKFARBE STICK-EREI Druckkosten1.0005001506012,49–2,29-,704,351,99-,653,951,49-,603,401,39-,502,95weitereFarben:sieheOnlineshop
StickereiHochwertigemöglich FÜR ALLE GUT SICHTBAR ZEITLOS FÜR JEDERMANN 217FREIZEIT | 1 SANDWICH-CAP Topmodern sind diese Baseballmützen aus 100% Baumwolle. Im Schirm ist jeweils eine Kontrastfarbe zwischen Ober- und Unterseite verarbeitet, daher das „Sandwich“-Schirm geformt und abgesteppt. Weitenregulierbar durch Klettverschluss. SP Spezialsiebdruck. Fläche: 90 x 50 mm Preis/Stk.: ab 60 Stück -,70 Werkzeugkosten: Siehe Serviceseiten. ST Stickerei. Fläche: auf Mütze, 1-4 farbig, 50 x 50 mm Preis/Stk.: ab 60 Stück 4,35 Werkzeugkosten einmalig 55,129 755 weiß ab 1,39 129 763 rot ab 1,39 129 771 blau ab 1,39 129 780 orange ab 1,39 140 164 schwarz ab 1,39 2 BASEBALLKAPPE
















































1 SWEATSHIRT „SET-IN“ „FRUIT OF THE LOOM“ Markenqualität von „Fruit of the Loom“. Nahtloser Rippstrick-Kragen, Schulter-zu-Schulter Nackenband. Rippstrick-Bündchen an Ärmeln und Bund. Doppelnaht an Armausschnitt und Kragen. Material: 80% Baumwolle + 20% Polyester (280 g/m2)
„FRUITKAPUZEN-JACKEOFTHELOOM“ Markenqualität aus 70% Baumwolle und 30% Polyesteranteil (280 g/m2). Hervorragende Verarbeitung. Innen flauschig angeraut. Durchgehender Reißverschluss, 2 aufgesetzte Taschen mit Doppelnaht. Rippstrickbündchen am Ärmelabschluss und Bund. SP Spezialsiebdruck. Fläche: auf Rücken, 270 x 270 mm. Oder Brust 100 x 100 mm Preis/Stk.: ab 8 Stück 2,50 ST Stickerei. Fläche: auf linke Brustseite, 1-4 farbig ca. 80 x 80 mm. Preis/Stk.: ab 8 Stück 4,95 Werkzeugkosten: Siehe Serviceseiten.
3
SP Spezialsiebdruck. Fläche: auf Rücken, 270 x 270 mm. Oder Brust, 100 x 100 mm Preis/Stk.: ab 15 Stück 1,90 Werkzeugkosten:
ROT ROT ROYAL ROYALSCHWARZ SCHWARZ hochwertigeStickereimöglich SCHWARZWEISS NAVY Lieferung nur für den gewerblichen Bedarf. Alle Preise zzgl. MwSt.218 | FREIZEIT
Siehe Serviceseiten. ST Stickerei. Fläche: auf linke Brustseite, 1-4 farbig, ca. 80 x 80 mm. Preis/Stk.: ab 15 Stück 3,95 Werkzeugkosten: einmalig 55,1 SWEAT-SHIRT „SET-IN“ „FRUIT OF THE LOOM“ ab9 45 2 „FRUITKAPUZEN-PULLIOFTHELOOM“ ab13 95 3 „FRUITKAPUZEN-JACKEOFTHELOOM“ ab19 95 GRÖSSE ROYAL SCHWARZ ROT M 275 667 275 706 275 747 L 275 675 275 714 275 755 XL 275 683275 722 275 763 XXL 275 691275 739 275 771 GRÖSSE ROYAL SCHWARZ ROT M 275 827 275 860 275 909 L 275 835 275 878 275 917 XL 275 843275 886275 925 XXL 275 851 275 894275 933 SIZE WEISS NAVY ROT SCHWARZ M 083 813 083 856083 897083 936 L 083 821 083 864 083 901 083 944 XL 083 830 083 872 083 910 083 952 XXL 083 848083 889083 928083 969 STÜCKAB WEISSPREIS PREISBUNT 1.DRUCKFARBE STICKEREI 2509,459,95-,853,9510010,5010,95-,954,105011,9512,201,304,251512,4513,451,904,75112,9513,95–DruckkostenweitereFarben:sieheOnlineshop AB STÜCK PREIS DRUCK 1. FARBE STICKEREI 1017,95118,95 1,90 4,75 2516,95 1,50 4,50 5014,95 1,30 4,25 10013,95 1,20 4,10 Druckkosten weitere Farben: siehe Onlineshop AB STÜCK PREIS DRUCK 1. FARBE STICKEREI 827,95129,95 2,50 4,95 2525,95 1,50 4,50 5022,95 1,30 4,25 10019,95 1,20 4,10 Druckkosten weitere Farben: siehe Onlineshop
2 KAPUZEN-PULLI „FRUIT OF THE LOOM“ Sportlicher, angenehm zu tragender Kapuzen-Pulli mit Markenqualität. Das besondere Extra ist die doppelte Kapuze mit Schnürkordel. Aufgesetzte Tasche mit Doppelnaht. Material: 70% Baumwolle und 30% Polyester (280 g/m2). Rippstrickbündchen an Ärmel und Bund. SP Spezialsiebdruck. Fläche: auf Rücken, 270 x 270 mm. Oder Brust, 100 x 100 mm Preis/Stk.: ab 10 Stück 1,90 ST Stickerei. Fläche: auf linke Brustseite, 1-4 farbig, ca. 80 x 80 mm. Preis/Stk.: ab 10 Stück 4,75 Werkzeugkosten: Siehe Serviceseiten.

























































































MELIERTGRAU MELIERTGRAUROT ROTNAVY SCHWARZ NAVYROYAL ROYAL SCHWARZ WEISS 219FREIZEIT | 2 SUPER PREMIUM T-SHIRT „FRUIT OF THE LOOM“ Klassisches Super Premium T-Shirt. Mit Rundhalsausschnitt. Kurzarm. Qualität: 100% Baumwolle. Grau: 97% Baumwolle, 3% Polyester. Weiß: 190 g/m2, farbig: 205 g/m2 SP Spezialsiebdruck. Fläche: Rücken: 270 x 270 mm. Brust: 100 x 100 mm Preis/Stk.: ab 25 Stück -,95 ST Stickerei. Fläche: auf linke Brustseite, 1-4 farbig, ca. 80 x 80 mm Preis/Stk.: ab 25 Stück 4,50 Werkzeugkosten: Siehe Serviceseiten. weiß 190 g ab 2,95 farbig 205 g ab 3,95 1 PREMIUM POLOSHIRT „FRUIT OF THE LOOM“ Unisex Premium Poloshirt von „Fruit of the Loom“. Knopfleiste mit 3 Knöpfen. Material: 100% Baumwolle. Grau: 97% Baumwolle, 3% Polyester. Farbig: 180 g/m 2, weiß 170 g/m 2 SP Spezialsiebdruck. Fläche: Rücken: 280 x 280 mm. Brust: 100 x 100 mm Preis/Stk.: ab 12 Stück 1,80 Werkzeugkosten: Siehe Serviceseiten. ST Stickerei. Fläche: auf linke Brustseite, 1-4 farbig, ca. 80 x 80 mm Preis/Stk.: ab 12 Stück 4,75 Werkzeugkosten: einmalig 55,1 „FRUITPOLOSHIRTOFTHE LOOM“ ab7 95 2 „FRUITT-SHIRTOF THE LOOM“ ab2 95 GRÖSSE GRAU MEL. ROT NAVY ROYAL SCHWARZ WEISS M 155 792 153 310153 230153 272153 352 153 192 L 155 805153 328153 248153 289153 369 153 205 XL 155 813 153 336153 256 153 297 153 377 153 213 XXL 155 821153 344153 264153 301153 385153 221 GRÖSSE GRAU MEL. NAVY SCHWARZ ROT ROYAL WEISS M 155 750153 432 153 553 153 512 153 473153 393 L 155 768 153 449 153 561 153 529 153 481153 408 XL 155 776 153 457153 570 153 537 153 490 153 416 XXL 155 784153 465153 588153 545153 504153 424 AB STÜCK STÜCKPREIS DRUCK 1. FARBE STICKEREI 1 11,45 12 10,95 1,80 4,75 50 9,95 1,20 4,25 100 8,95 -,95 4,10 200 7,95 -,85 3,75 Druckkosten weitere Farben: siehe Onlineshop AB STÜCKSTÜCKPREIS WEISS STÜCKPREIS BUNT DRUCK 1. FARBE STICKEREI 1 4,95 5,95 25 4,45 5,25 -,95 4,50 100 3,95 4,95 -,85 4,10 300 3,75 4,45 -,75 3,75 600 2,95 3,95 -,70 3,20 Druckkosten weitere Farben: siehe Onlineshop






































































































GRÖSSE WEISS SCHWARZ ROYAL GRÜN ROT GRAU S 222 061222 115222 166222 211222 262222 318 M 222 070222 123222 174222 220 222 279 222 326 L 222 088222 131222 182222 238 222 287 222 334 XL 222 096 222 140222 199222 246222 295222 342 XXL 222 107222 158222 203222 254222 300222 359 MEN BASIC POLO GRÖSSE WEISS SCHWARZ ROYAL GRÜN ROT GRAU S 222 367222 414222 463222 519222 560222 617 M 223 419 222 422 223 443 222 527 222 578222 625 L 222 383222 439222 480222 535222 586222 633 XL 223 427223 435 222 498222 543222 594222 641 XXL 222 406222 455222 502222 551222 609 222 650 LADY BASIC POLO AB STÜCK PREIS DRUCK 1. FARBE STICKEREI 129,95110,95 2,95 4,95 259,45 2,25 4,50 508,95 1,75 4,25 1007,95 1,45 4,10 2007,45 -,95 3,75 5006,95 -,75 3,40 Druckkosten weitere Farben: siehe Onlineshop AB STÜCK PREIS DRUCK 1. FARBE STICKEREI 815,95116,95 3,95 4,95 2014,95 2,45 4,50 5013,95 1,75 4,25 10012,95 1,45 4,10 20011,95 -,95 3,75 50010,95 -,75 3,40 Druckkosten weitere Farben: siehe Onlineshop grau royalschwarzweißgrünrot royalschwarzweißgrüngrau rot orange weiß 1 POLOSHIRT BASIC MIT BIO-BAUMWOLLE „JAMES & NICHOLSON“ Klassisches Poloshirt. Oberstoff (180 g/m²): 100% Baumwolle aus biologischem Anbau. Feine Piqué-Qualität aus 100% gekämmter, ringgesponnener BIO-Baumwolle. Gestrickter Polokragen und Armbündchen, 2 Knöpfe (Men) bzw. 4 Knöpfe (Lady) Ton in Ton, Seitenschlitze. Lady mit tailliertem Schnitt. SP Spezialsiebdruck. Fläche: Rücken: 280 x 280 mm. Brust: 100 x 100 mm Preis/Stk.: ab 8 Stück 3,95 Werkzeugkosten: Siehe Serviceseiten. ST Stickerei. Fläche: auf linke Brustseite, 1-4 farbig, ca. 80 x 80 mm Preis/Stk.: ab 8 Stück 4,95 Werkzeugkosten: einmalig 55,-
2 T-SHIRT BASIC MIT BIO-BAUMWOLLE „JAMES & NICHOLSON“ T-Shirt in klassischer Form. Oberstoff (Men 140 g/m², Lady 120 g/m²): 100% Baumwolle aus biologischem Anbau. 100% gekämmte, ringgesponnene BIOBaumwolle, Single Jersey, Rundhalsausschnitt, Bündchen mit Elasthan. SP Spezialsiebdruck.
Fläche: Rücken: 270 x 270 mm. Brust: 100 x 100 mm Preis/Stk.: ab 12 Stück 2,95 Werkzeugkosten: Siehe Serviceseiten. ST Stickerei. Fläche: auf linke Brustseite, 1-4 farbig, ca. 80 x 80 mm Preis/Stk.: ab 12 Stück 4,95 Werkzeugkosten: einmalig 55,1 POLOSHIRT BASIC MIT BIO-BAUMWOLLE ab 10 95 2 T-SHIRT BASIC MIT BAUMWOLLEBIOab 6 95 GRÖSSE WEISS SCHWARZ ROT ROYAL GRÜN ORANGE S 221 462 221 518 221 567 221 614 221 663 221 719 M 221 479 221 526 221 575 221 622 221 671 221 727 L 221 487 221 534 221 583221 639221 680221 735 XL 221 495221 542 221 591 221 647 221 698 221 743 XXL 221 500 221 559 221 606 221 655 221 702 221 751 GRÖSSE WEISS SCHWARZ ROT ROYAL GRÜN ORANGE S 221 760 221 817 221 868 221 913 221 964 222 012 M 221 778 221 825 221 876 221 921 221 972 222 029 L 221 786 221 833221 884221 930 221 989 222 037 XL 221 794 221 841 221 892 221 948 221 997 222 045 XXL 221 809221 850 221 905 221 956 222 004222 053 MEN BASIC T-SHIRTLADY BASIC T-SHIRT BASICLADY BASICMEN BASICLADY BASICMEN rotweißschwarzroyalgrün royalschwarzrotgrünorange Preistabelle für Polo Lady und Men Preistabelle für Basic T-Shirt Lady und Men Lieferung nur für den gewerblichen Bedarf. Alle Preise zzgl. MwSt.220 | FREIZEIT






























BIO-BAUMWOLLE MIT GUTEM GEWISSEN UND ZU FAIREN PREISEN AB STÜCK PREIS DRUCK 1. FARBE STICKEREI 434,95135,45 5,95 6,95 1034,45 3,95 4,95 3032,95 2,25 4,50 6030,95 1,75 4,25 15027,95 1,35 3,95 25025,95 -,95 3,75 Druckkosten weitere Farben: siehe Onlineshop HOODYMENHOODYLADY grün grau royal rot schwarzweiß rotgrau royal grün schwarzweiß royal 1 HOODY MIT BIO-BAUMWOLLE „JAMES & NICHOLSON“ Kapuzensweater mit Raglanärmeln. Oberstoff (300 g/m²): 85% gekämmte, ringgesponnene BIO-Baumwolle, 15% Polyester. Hochwertige Sweat-Qualität mit angerauter Innenseite, doppellagige Kapuze mit Kordelzug, seitliche Teilungsnähte im Vorderteil, Kängurutasche, Bündchen mit Elasthan und Tear off!® - Label. Leicht tailliert SP Spezialsiebdruck. Fläche: Rücken: 270 x 270 mm. Brust: 100 x 100 mm, Preis/Stk.: ab 4 Stück 5,95 Werkzeugkosten: Siehe Serviceseiten. ST Stickerei. Fläche: auf linke Brustseite, 1-4 farbig, ca. 80 x 80 mm Preis/Stk.: ab 4 Stück 6,95 Werkzeugkosten: einmalig 55,1 HOODY BIO-BAUMWOLLEMIT ab 25 95 GRÖSSE WEISS SCHWARZ ROT ROYAL GRÜN GRAU S 222 965 223 015 223 066 223 111 223 162 223 218 M 222 973 223 023 223 074 223 120 223 179 223 226 L 222 981 223 031 223 082 223 138 223 187 223 234 XL 222 990 223 040223 099 223 146 223 195 223 242 XXL 223 007223 058 223 103 223 154 223 200 223 259 GRÖSSE WEISS SCHWARZ ROT ROYAL GRÜN GRAU S 222 668222 713222 764222 810222 869222 916 M 222 676222 721222 772222 828 222 877 222 924 L 222 684222 730222 789222 836222 885222 932 XL 222 692222 748 222 797 222 844222 893222 949 XXL 222 705222 756222 801222 852 223 460 222 957 LADY HOODY MEN HOODY 221FREIZEIT |

































Leichtschnellmitgenommen,ausgefaltet SCHWARZMARINE schnell ausgefaltet Lieferung nur für den gewerblichen Bedarf. Alle Preise zzgl. MwSt.222 | FREIZEIT KISSENKUSCHELWEICH&DECKE2IN1 3 2-IN-1 KISSENFLEECEDECKE/ ab 6 95 3 2-IN-1 FLEECEDECKE/KISSEN Dieses flauschige Kissen ist ein echter Verwandlungskünstler. Denn im Nu wird durch Öffnen und Schliessen des Reißverschlusses aus dem Kissen eine Kuscheldecke und umgekehrt. Maße: geschlossen/Kissen 31 x 29 x 8cm, offen/Decke 190 x 120 cm SP Spezialdruck. Fläche: 200 x 180 mm Preis/Stk.: ab 15 Stück 1,95 Werkzeugkosten: Siehe Serviceseiten. 164 343 blau ab 6,95 164 351 rot ab 6,95 164 360 grau ab 6,95 164 378 grün ab 6,95 167 825 orange ab 6,95 STÜCKAB STÜCK-PREIS 1.DRUCKFARBE 1 9,95 15 8,95 1,95 50 8,45 1,75 150 7,95 1,50 500 6,95 1,25 Druckkosten weitere Farben: siehe Onlineshop 2 FLEECEDECKE Ob beim Picknick oder im Open-AirKino – diese weiche Decke aus Fleece ist mit ihrem praktischen Tragegriff ein idealer Wärmespender, wenn es unterwegs auch mal kühler wird. Maße: geschlossen 33 x Ø 13 cm, offen/Decke 180 x 130 cm SP Spezialsiebdruck. Fläche: 90 x 30 Preis/Stk.:mmab 20 Stück 1,95 Werkzeugkosten: Siehe Serviceseiten. ST Stickerei. Fläche: auf Decke 150 x 100 mm Preis/Stk.: ab 20 Stück 4,50 Einmalige Werkzeugkosten: 55,195 520 blau ab 4,95 195 538 grau ab 4,95 195 546 rot ab 4,95 195 554 grün ab 4,95 2 FLEECEDECKE ab 4 95 STÜCKAB STÜCK-PREIS 1.DRUCKFARBE STICKEREI 1.000500150752017,95–7,451,954,506,951,754,106,451,603,955,951,353,404,95-,852,95 GRÖSSE MARINE SCHWARZ M 283 917 283 878 L 283 925283 886 XL 283 933 283 894 XXL 283 941 283 909 1 REGENJACKE „SIROCCO“ Diese sportliche Regenjacke gibt es zu einem unschlagbaren PreisLeistungsverhältnis. Wind- und wasserabweisend mit durchgehendem Reißverschluss. 100% Nylon. Kapuze mit Zugkordel im Kragen integriert. Elastische Ärmelbündchen. Zugkordel am Bund. Eine seitliche Eingriffstasche mit Zip. SP Spezialsiebdruck. Fläche: Rücken: 270 x 270 mm Linke Brustseite: 100 x 100 mm Preis/Stk.: ab 10 Stück 2,95 Werkzeugkosten: Siehe Serviceseiten. STÜCKAB STÜCK-PREIS 1.DRUCKFARBE 1013,75114,25 2,95 5013,25 1,65 10012,75 1,45 20011,25 1,35 5009,95 -,95 Druckkosten weitere Farben: siehe Onlineshop 1 „SIROCCO“REGENJACKE ab9 95






























































250 111111ANHÄNGERSCHLÜSSEL-304sortiert290hellblau 219.-WERBETIPP* 1 ANHÄNGERFILZ-SCHLÜSSELab0 35 223FREIZEIT | 3 „GARAFA“FILZTASCHE ab 1 59 2 FILZ TRAGETASCHE Tasche aus hochwertigem Kunstfilz mit zwei Tragegriffen, welche den perfekten Hintergrund für eine Werbebotschaft oder Ihr Firmenlogo bietet. Pfiffig: Der Klettverschluss sorgt dafür, dass nichts aus der Tragetasche herausfällt. Maße: 28,5 x 38 x 8 cm Highlights: mit Kettverschluß, im kompakten Format. SP Spezialsiebdruck. Fläche: 200 x 100 mm Preis/Stk.: ab 30 Stück 1,40 Werkzeugkosten: Siehe Serviceseiten. 135 777 blau ab 2,95 2 TRAGETASCHEFILZ ab2 95 STÜCKAB STÜCK-PREIS 1.DRUCKFARBE 1 4,35 30 4,05 1,40 100 3,75 -,99 500 3,35 -,90 1.000 2,95 -,80 Druckkosten weitere Farben: siehe Onlineshop 3 FILZTASCHE „GARAFA“ Der perfekte „Wintermantel“ für die Weinflasche, ob süß, prickelnd oder trocken. Und wenn die Flasche dann ausgetrunken ist, bleibt die stabile Filztasche zur weiteren Verwendung bereit. Maße: 10 x 30 x 10 cm SP Spezialsiebdruck. Fläche: Preis/Stk.: ab 60 Stück: -,95 Werkzeugkosten: siehe Serviceseiten. 146 005 ab 1,59 STÜCKAB STÜCK-PREIS 1.DRUCKFARBE 1 2,29 60 2,19 -,95 150 2,09 -,90 250 1,79 -,85 1.0001,59 -,75 Druckkosten weitere Farben: siehe Onlineshop 1 FILZ-SCHLÜSSELANHÄNGER Filz-Schlüsselanhänger in trendigen Farben. Die große Druckfläche lässt Ihre Werbung optimal zur Geltung kommen. Maße: ca. 13,5 x 3 cm Material: Filz mit Metallring SP Spezialsiebdruck. Fläche: ca. 80 x 22 mm Preis/Stk.: ab 250 Stück -,32 Werkzeugkosten: Siehe Serviceseiten. 165 006 grau ab -,35 195 909 dunkelblau ab -,35 110 002 hellblau ab -,35 110 019 rot ab -,35 110 027 schwarz ab -,35 110 035 orange ab -,35 110 043 grün ab -,35 STÜCKAB STÜCK-PREIS 1.DRUCKFARBE 1 -,49 250 -,46 -,32 500 -,43 -,30 1.500 -,41 -,29 2.500 -,38 -,28 5.000 -,35 -,27 Druckkosten weitere Farben: siehe Onlineshop FILZ IST DER BESTE HINTERGRUND FÜR IHRE WERBUNG * Komplettpreis inklusiv einfarbigem, einseitigen Werbeaufdruck in Standardschrift















































































Stück 1,30
Trink-
x
Aus Kunststoff,
cm
Siehe Serviceseiten. 211 284 ab 2,95 STÜCKAB STÜCK-PREIS 1.DRUCKFARBE 1 4,25 30 3,95 1,30 60 3,75 -,95 150 3,55 -,70 300 3,35 -,65 800 2,95 -,50 Druckkosten weitere Farben: siehe Onlineshop 3 FALTBARTRINKFLASCHE ab2 95 Viel Platz fürLeckerli & Co Werbedruck aufder Unterseite mit Lupe
integrierten
Ob bei langen Ausflügen, auf Reisen oder an heißen Tagen Hunde benötigen auch unterwegs ausreichend Flüssigkeit. Diese auslaufsichere flasche (500 ml) hat einen Trinknapf, der bei Bedarf einfach heruntergeklappt wird. mit Handschlaufe. 7 x 25,5 W Werbedruck. 60 15 seitlich Preis/Stk.: ab 30 Werkzeugkosten:
Lieferung nur für den gewerblichen Bedarf. Alle Preise zzgl. MwSt.224 | FREIZEIT
hochklappeneinfach
2 SNACK BAG Perfekt für das Training des vierbeinigen Lieblings während der täglichen Spaziergänge. In der verschließbaren, wasserabweisenden Snack Bag mit Karabinerhaken können die Belohnungsleckerlis immer griffbereit an Leine, Gürtel oder Tasche befestigt werden. Maße: Ø 14 x 10 cm SP Spezialdruck. Fläche: 60 x 50 mm auf eine Preis/Stk.:Seiteab 25 Stück 1,60 Werkzeugkosten: Siehe Serviceseiten. 211 276 ab 3,95
–
Maße: 7 x
Fläche:
einmalig 29,211 305 ab -,79 STÜCKAB STÜCK-PREIS 1.DRUCKFARBE 1 4,95 25 4,65 1,60 60 4,45 1,40 1504,25 1,20 350 3,95 -,95 Druckkosten weitere Farben: siehe Onlineshop STÜCKAB STÜCK-PREIS 1.DRUCKFARBE DIGITAL-DRUCK Druckkosten1.00050025010011,29–1,19-,38-,801,09-,35-,75-,99-,30-,70-,89-,25-,602.500-,79-,20-,45weitereFarben:sieheOnlineshop 2 SNACK BAG ab3 95 1 ZECKENKARTE MIT LUPE BULLY ab0 79 NEUES SORTIMENT FÜR FELLNASEN TIERISCH WERBEN! 4 REISENAPF FALTBAR COCO Dieser faltbare Futternapf aus Kunststoff ist ideal für die Versorgung des Hundes unterwegs. Nach Gebrauch lässt er sich ganz flach zusammenfalten und mit dem Metallkarabiner an Taschen & Co. befestigen. Maße: Ø 14 x 2 cm (offen 5 cm) W Werbedruck. Fläche: 40 x 20 mm auf Preis/Stk.:Unterseiteab40 Stück -,90 Werkzeugkosten: Siehe Serviceseiten. 211 268 ab 2,65 STÜCKAB STÜCK-PREIS 1.DRUCKFARBE 1 3,75 40 3,45 -,90 1003,25 -,80 250 2,95 -,70 5002,65 -,50 Druckkosten weitere Farben: siehe Onlineshop 4 REISENAPF FALTBAR COCO ab2 65 DRUCK4C
mm
3 TRINKFLASCHE FALTBAR
1 ZECKENKARTE MIT LUPE BULLY Hunde streifen durch Wälder und Wiesen, da lassen sich Zeckenstiche kaum verhindern. Umso wichtiger ist eine schnelle und sichere Entfernung der Parasiten. Diese Zeckenkarte mit verschieden großen Auslassungen passt in jede Handtasche und erleichtert dank Lupe das schnelle Auffindenund Herausziehen von Zecken. Maße: 8 x 5,4 cm W Werbedruck. Fläche: 40 x 35 mm auf Oberseite Preis/Stk.: ab 100 Stück -,38 Werkzeugkosten: Siehe Serviceseiten. D Digitaldruck 4c. Fläche: 40 x 35 mm auf Oberseite Preis/Stk.: ab 100 Stück -,80 Datenhandling:
























































































































































































RUND UM‘S RAD 1 SATTELSCHUTZ AUS RPET Perfekt für die Regensaison und um Ihre Werbebotschaft sympatisch zu platzieren! Universal-Satteldecke aus recyceltem PET, der Umwelt zuliebe. Maße: 24,5 x 22,0 x 7,0 cm SP Spezialsiebdruck. Fläche: 70 x 70 Preis/Stk.:mmab 200 Stück -,25 Werkzeugkosten: Siehe Serviceseiten. 220 496 schwarz ab -,45 220 507 weiß ab -,45 220 515 blau ab -,45 220 523 rot ab -,45 2 RINGRING FAHRRADKLINGEL Klangvolle Fahrradklingel. Oberseite aus Aluminium mit eingelassenem silbernen Papierklebepunkt für Ihre Werbeanbringung. Unterseite aus ABS. Maße: : Ø 5,5 x 5 cm W Werbedruck. Fläche: Oberseite: Ø 25 mm Preis/Stk.: ab 100 Stück -,35 Werkzeugkosten: Siehe Serviceseiten. 220 531 blau ab -,89 220 540 schwarz ab -,89 220 558 silber ab -,89 STÜCKAB STÜCKPREIS 1.DRUCKFARBE 1 -,75 200 -,69 -,25 500 -,65 -,22 1.000 -,59 -,20 2.500 -,54 -,18 5.000 -,49 -,17 10.000 -,45 -,16 Druckkosten weitere Farben: siehe Onlineshop STÜCKAB STÜCKPREIS DRUCK1C 1 1,50 100 1,35 -,35 300 1,25 -,30 600 1,15 -,25 1.500 1,05 -,20 2.500 -,98 -,17 5.000 -,89 -,14 1 AUSSATTELSCHUTZRPET ab 0 45 2 FAHRRADKLINGELRINGRING ab 0 89 UP 225FREIZEIT | 3 FAHRRADLENKERTASCHE Fahrradlenkertasche aus Polyester und PVC mit separatem Fach an der Oberseite für ein Mobildtelefon. Der Touchscreen des Telefons kann durch die PVC-Abdeckung weiterhin benutzt werden. Maße: 19,5 x 10 x 9 cm SP Spezialsiebdruck. Fläche: 70 x 25 Preis/Stk.:mmab 20 Stück 1,50 Werkzeugkosten: Siehe Serviceseiten. 214 439 ab 3,95 4 FAHRRAD-REPARATURSET Ein Muss für Alle die mit dem Fahrrad unterwegs sind. Reparaturset mit 1 Schraubenschlüssel, 2 Reifenheber, 1 Klebstoff, 2 Ventilkappen, 2 Ventile, Sandpapier und 5 Flicken. Große Werbeanbringung auf transparenter PP-Box Maße: 12 x 9 x 2,8 cm W Werbedruck. Fläche: 50 x 50 mm Preis/Stk.: ab 40 Stück -,85 Werkzeugkosten: Siehe Serviceseiten. 214 447 ab 1,95 STÜCKAB STÜCKPREIS 1.DRUCKFARBE 1 6,95 20 6,45 1,50 50 5,95 1,20 100 5,45 -,95 200 4,95 -,60 500 4,45 -,50 1.000 3,95 -,40 Druckkosten weitere Farben: siehe Onlineshop STÜCKAB STÜCKPREIS 1.DRUCKFARBE 1 3,25 40 2,95 -,85 100 2,75 -,70 250 2,55 -,65 500 2,35 -,60 1.000 2,15 -,50 2.500 1,95 -,40 Druckkosten weitere Farben: siehe Onlineshop 3 FAHRRADLENKERTASCHE ab 3 95 4 FAHRRAD-REPARATURSET ab 1 95
























































NEU NEU Lieferung nur für den gewerblichen Bedarf. Alle Preise zzgl. MwSt.226 | KALENDER 1 „COLOURSWANDKALENDEROFLIFE “ Wie bunt unsere Welt ist, fällt erst durch den Kontrast zu einer einfarbigen Umgebung auf. So auch bei den kunstvollen Aufnahmen in diesem Kalender, die Klassiker wie die roten Telefonzellen in der Londoner Innenstadt und weitere farbige Highlights vor einer schwarz-weißen Kulisse glänzend in Szene setzen. Maße: 58 x 39 cm O Offsetdruck. Fläche: 400 x 40 mm Preis/Stk.: ab 10 Stück 3,95 Werkzeugkosten: Siehe Serviceseiten. 223 494 ohne Druck ab 9,95 223 509 für Druck ab 9,95 STÜCKAB STÜCK-PREIS 1.DRUCKFARBE 1 13,95 10 13,45 3,95 30 12,95 2,95 50 12,45 2,45 100 11,95 1,95 200 10,95 1,25 400 9,95 -,85 Druckkosten weitere Farben: siehe Onlineshop 1 „COLOURSWANDKALENDEROFLIFE ab 9 95 2 „COLOURWANDKALENDERTRIPLETS “ Die kunstvoll zusammengestellten Colour Triplets in diesem Kalender sind ein Wandschmuck der Superlative. Jedes Monatsblatt zeigt eine neue, perfekt abgestimmte Farbsymphonie aus Detailfotografien international bekannter Topfotografen. Maße: 28,5 x 69 cm O Offsetdruck. Fläche: 260 x 40 mm Preis/Stk.: ab 10 Stück 3,95 Werkzeugkosten: Siehe Serviceseiten. 223 517 ohne Druck ab 8,95 223 525 für Druck ab 8,95 STÜCKAB STÜCK-PREIS 1.DRUCKFARBE 1 12,95 10 12,45 3,95 30 11,95 2,95 50 11,45 2,45 100 10,95 1,95 200 9,95 1,25 400 8,95 -,85 Druckkosten weitere Farben: siehe Onlineshop 2 „COLOURWANDKALENDERTRIPLETS ab 8 95 58 cm 39 cm































2 „EMOTION“BILDKALENDER ab 0 89 1 „MOTIVATIONTISCHQUERKALENDER“
kleiner Kalender mit großer Wirkung, der mit gezielten motivierenden Zitaten auf keinem Schreibtisch fehlen sollte. Mit viel Platz für die tägliche Terminplanung, Listen für wöchentliche To-dos und Prioritäten sowie Raum für Notizen und Ideen. Maße: 29,8 x 10,5 cm W Werbedruck. Fläche: 260 x 17 mm Preis/Stk.: ab 20 Stück 1,60 Werkzeugkosten: Siehe Serviceseiten. 223 533 ohne Druck ab 4,95 223 541 für Druck ab 4,95 STÜCKAB STÜCK-PREIS 1.DRUCKFARBE 1 6,45 20 6,25 1,60 50 5,95 1,40 100 5,45 1,20 250 5,25 1,500 4,95 -,90 Druckkosten weitere Farben: siehe Onlineshop 1 „MOTIVATIONTISCHQUERKALENDER“ ab 4 95
8011,951,60
„Die Natur liebt es, sich zu verbergen“ sagte Heraklit. Doch wer sie sucht, empfindet besondere Emotionen und Gedanken. 12 Reflexionen von Philosophen begleiten bei diesem großen Bildkalender faszinierende Aufnahmen unserer Erde. Maße: ca. 24 x 37,5 cm W Werbedruck. Fläche: 225 x 35 mm Preis/Stk.: ab 80 Stück -,70 Werkzeugkosten: Siehe Serviceseiten. 211 926 ohne Druck ab -,89 211 934 für Druck ab -,89 STÜCKAB STÜCK-PREIS 1.DRUCKFARBE -,70 250 1,50 -,60 500 1,35 -,55 1.000 1,20 -,50 2.500 -,99 -,40 5.000 -,89 -,35 Druckkosten weitere Farben: siehe Onlineshop
NEU 227KALENDER | 2 „BILDKALENDEREMOTION”
Ein















Lieferung nur für den gewerblichen Bedarf. Alle Preise zzgl. MwSt.228 | KALENDER 1 WUNDERWELT KUNSTKALENDER Mit Matisse, Chagall, Klimt, Klee, Blam, Macke und Kandinsky. Große Monatszahl und übersichtliches Kalendarium. 12 Kalenderblätter und 1 Deckblatt mit verschiedenen Motiven. Zusätzlich 1 Blatt mit Erklärungen. Einzelkarton. Maße: 48 x 64 cm. W Werbedruck. Fläche: 350 x 40 mm Preis/Stk.: ab 6 Stück 4,95 Werkzeugkosten: Siehe Serviceseiten. 029 279 ohne Druck ab 18,95 153 615 für Druck ab 18,95 STÜCKAB STÜCK-PREIS 1.DRUCKFARBE 6121,9520,95 4,95 15 19,95 2,95 50 18,95 1,50 Druckkosten weitere Farben: siehe Onlineshop 1 KUNSTKALENDERWUNDERWELT ab 18 95 2 „HYGGELIGSTREIFENKALENDER“ Hygge ist ein Lebensgefühl und wichtiger Bestandteil der dänischen Mentalität. Dieser Kalender zeigt jeden Monat eine inspirierende Illustration. Die Motive vereinen Themen rund um Mensch, Natur, Musik und Kunst. Sie vermitteln Ruhe und Gelassenheit –ein wesentliches Merkmal, wenn es darum geht den schnelllebigen Alltag hinter sich zu lassen. Das Abstrakte sowie die vielen gezeichneten Details, die sich übrigens auch im Kalendarium wieder finden, regen den Betrachter an, kurz Inne zu halten und nachzudenken. Mit 100-jährigem Kalender, Mondphasen, Tipp des Monats und abtrennbarer Postkarte. Maße: 13 x 53,5 cm W Werbedruck. Fläche: 100 x 40 mm Preis/Stk.: ab 100 Stück -,50 Werkzeugkosten: Siehe Serviceseiten. 223 857 ohne Druck ab -,89 223 865 für Druck ab -,89 2 „HYGGELIGSTREIFENKALENDER“ ab 0 89 STÜCKAB STÜCK-PREIS 1.DRUCKFARBE 1 1,65 100 1,55 -,50 250 1,39 -,45 1.000 1,19 -,40 2.000 -,99 -,35 3.000 -,89 -,25 Druckkosten weitere Farben: siehe Onlineshop NEU


























EXTRA GROSSE KALENDER 69 cm hoch 58 cm breit 229KALENDER | 1 „WANDKALENDERMEERFERNWEH” Nicht immer kann man seiner Reiselust so einfach nachgehen und sich zu seinen Lieblingsorten am Meer auf den Weg machen. Dafür kann man herrliche Momente am Meer mit diesem Kalender in den eigenen vier Wänden genießen. Ein grandioser Wandschmuck für alle, deren Herzen beim Klang der Wellen, salziger Luft und sonnigen Stränden höherschlagen. Maße: ca. 58 x 39 cm O Offsetdruck. Fläche: 400 x 40 mm Preis/Stk.: ab 10 Stück 3,95 Werkzeugkosten: Siehe Serviceseiten. 211 862 ohne Druck ab 9,95 211 879 für Druck ab 9,95 STÜCKAB STÜCK-PREIS 1.DRUCKFARBE 1 13,95 10 13,45 3,95 30 12,95 2,95 50 12,45 2,45 100 11,95 1,95 200 10,95 1,25 400 9,95 -,85 Druckkosten weitere Farben: siehe Onlineshop 1 „MEERWANDKALENDERFERNWEH“ ab 9 95 2 „WANDKALENDERBÄUME” Himmelsstürmer und Symbole des Lebens: Bäume sind faszinierende Wesen, die mit dem Alter immer mehr an Persönlichkeit gewinnen. 12 besondere Exemplare aus allen Regionen der Erde wurden für diesen Kalender ausgewählt. Brillante Fotos und einzigartige Stimmungen bringen die Seele der Bäume zu ihren Betrachtern nach Hause. Maße: ca. 28,5 x 69 cm O Offsetdruck. Fläche: 260 x 40 mm Preis/Stk.: ab 10 Stück 3,95 Werkzeugkosten: Siehe Serviceseiten. 211 846 ohne Druck ab 8,95 211 854 für Druck ab 8,95 STÜCKAB STÜCK-PREIS 1.DRUCKFARBE 1 12,95 10 12,45 3,95 30 11,95 2,95 50 11,45 2,45 100 10,95 1,95 200 9,95 1,25 400 8,95 -,85 Druckkosten weitere Farben: siehe Onlineshop 2 „BÄUMEWANDKALENDER“ ab 8 95

























EINZIGARTIGE REISE ZU DEN NATURPARADIESENSCHÖNSTEN 1 WANDKALENDER NATURPARADIESE“„BEDROHTE Atemberaubende Gletscher, bunte Korallenriffe, faszinierende Wüstenund Wasserlandschaften, Bergwelten und Regenwälder - allesamt einzigartige Ökosysteme, die durch den Klimawandel und menschliche Eingriffe in Gefahr sind. Mit großartigen Aufnahmen und spannenden Kurztexten ist dieser Kalender nicht nur ein toller Wandschmuck, sondern auch ein Plädoyer für den Schutz der letzten unberührten Naturparadiese der Erde. Maße: 44 x 36 cm O Offsetdruck. Fläche: 350 x 40 mm Preis/Stk.: ab 50 Stück 1,95 Werkzeugkosten: Siehe Serviceseiten. 211 887 ohne Druck ab 3,95 211 895 für Druck ab 3,95 STÜCKAB STÜCK-PREIS 1.DRUCKFARBE WEITEREJEDEFARBE 5015,955,55 1,95-,80 100 5,25 1,35-,60 200 4,95 -,70-,40 500 4,45 -,40-,20 1.000 3,95 -,25-,10 Druckkosten weitere Farben: siehe Onlineshop 1 WANDKALENDER „ BEDROHTE NATURPARADIESE“ ab 3 95 Lieferung nur für den gewerblichen Bedarf. Alle Preise zzgl. MwSt.230 | KALENDER 2 „REISETRÄUME“3-MONATS-WANDKALENDER 12 Kalenderblätter mit wunderschönen Panoramen aus aller Welt. 3-MonatsKalendarium mit Datumsschieber, 4-sprachiges Kalendarium. Schwarze Kopfklappe für Werbetext. Maße: aufgeklappt 30 x 74 cm O Offsetdruck. Fläche: 270 x 35 mm Preis/Stk.: ab 30 Stück 1,65 Werkzeugkosten: Siehe Serviceseiten. 093 524 ohne Druck ab 4,95 093 532 für Druck ab 4,95 2 3-MONATS-WANDKALENDER „REISETRÄUME“ ab 4 95 STÜCKAB STÜCK-PREIS 1.DRUCKFARBE 3016,956,75 1,65 100 5,95 1,45 250 5,25 -,85 500 4,95 -,65 Druckkosten weitere Farben: siehe Onlineshop



































231KALENDER | 3 „WUNDERWANDKALENDERDERWELT 2023“ Bildwandkalender mit Hochglanzbildern aus der ganzen Welt auf schwarzem Fotopapier. Maße: 44 x 36 cm O Offsetdruck. Fläche: 350 x 40 mm Preis/Stk.: ab 30 Stück 2,95 Werkzeugkosten: Siehe Serviceseiten. 282 720 ohne Druck ab 3,99 282 738 für Druck ab 3,99 3 „WUNDER DER WELT“ ab 3 99 1 „SAVEWANDKALENDEROURWORLD” Unsere Erde hat viele bedrohte Regionen. Das sich verändernde Weltklima hat Auswirkungen auf die Alpenregionen ebenso wie auf den tropischen Regenwald oder die Arktis mit Ihren Eisbären. Dieser Kalender zeigt jeden Monat beispielhaft ein anderes Gebiet unserer Erde in wunderschönen Bildern und erläutert anschaulich die dort bestehenden Probleme. Maße: 44 x 36 cm O Offsetdruck. Fläche: 350 x 40 mm Preis/Stk.: ab 30 Stück 2,95 Werkzeugkosten: Siehe Serviceseiten. 082 909 ohne Druck ab 3,99 082 925 für Druck ab 3,99 STÜCKAB STÜCK-PREIS 1.DRUCKFARBE 3015,955,60 2,95 50 5,10 2,50 100 4,85 1,50 250 4,65 -,80 500 4,25 -,40 1.000 3,99 -,30 Druckkosten weitere Farben: siehe Onlineshop 1 „SAVEWANDKALENDERTHEWORLD“ ab 3 99 2 „UNESCO-WELTERBESTÄTTEN“WANDKALENDER 12 der schönsten Stätten des von der UNESCO erfassten Welterbes zeigt dieser hochwertige Wandkalender. So z. B. die Namib-Wüste in Namibien oder der Hafen von Stralsund. Ihre Kunden werden über so viel Schönheit staunen. Maße: 44 x 36 cm O Offsetdruck. Fläche: 350 x 40 mm Preis/Stk.: ab 30 Stück 2,95 Werkzeugkosten: Siehe Serviceseiten. 082 886 ohne Druck ab 3,99 082 894 für Druck ab 3,99 2 „UNESCOWANDKALENDERWELTERBESTÄTTEN“ ab 3 99 STÜCKAB STÜCK-PREIS 1.DRUCKFARBE 3015,955,60 2,95 50 5,10 2,50 100 4,85 1,50 250 4,65 -,80 500 4,25 -,40 1.000 3,99 -,30 Druckkosten weitere Farben: siehe Onlineshop STÜCKAB STÜCK-PREIS 1.DRUCKFARBE 3015,955,60 2,95 50 5,10 2,50 100 4,85 1,50 250 4,65 -,80 500 4,25 -,40 1.000 3,99 -,30 Druckkosten weitere Farben: siehe Onlineshop



































Lieferung nur für den gewerblichen Bedarf. Alle Preise zzgl. MwSt.232 | KALENDER 3 „FASZINATIONGEO-BILDKALENDERNATUR“ Die Natur ist ein Architekt mit seltsamen Launen und erstaunlichen Gaben. Genial, verrückt, verblüffend und faszinierend, eine Hommage an die Natur in 12 Fotografien, ganz in der Tradition der großen GEO- Bildkalender. Maße: inkl. Kopfklappe ca. 22 x 52 cm. W Werbedruck. Fläche: 200 x 40 mm auf schwarze Kopfklappe Preis/Stk.: ab 12 Stück 3,50 Werkzeugkosten: Siehe Serviceseiten. 136 309 ohne Druck ab 8,95 136 317 für Druck ab 8,95 STÜCKAB STÜCK-PREIS 1.DRUCKFARBE 12111,9511,45 3,50 50 10,95 2,65 100 9,95 1,95 300 8,95 1,45 Druckkosten weitere Farben: siehe Onlineshop 3 GEO-WANDKALENDER „FASZINATION NATUR“ ab 8 95 1 „MEERBLICK“GEO-WANDKALENDER Faszination Meer – wo das Land zu Ende ist, präsentieren sich von Wind und Wellen geformte Küstenlandschaft, weite Wasser und unendliche Horizonte. 12 wunderbare Küstenblicke, die die Reiselust wecken. Maße: inkl. Kopfklappe ca. 58 x 36 cm. W Werbedruck. Fläche: auf schwarze Kopfklappe, 350 x 40 mm Preis/Stk.: ab 8 Stück 3,95 Werkzeugkosten: Siehe Serviceseiten. 153 883 ohne Druck ab 14,95 153 891 für Druck ab 14,95 STÜCKAB STÜCK-PREIS 1.DRUCKFARBE 8120,9519,65 3,95 20 18,95 3,25 50 18,45 2,65 100 16,45 1,95 200 14,95 1,45 Druckkosten weitere Farben: siehe Onlineshop 2 „SEHNSUCHTSORTE“GEO-WANDKALENDER Magische Momente entfalten sich an ganz besonderen Orten. Die Geo-Fotoreporter haben für Sie 12 unvergessliche, atemberaubende Sehnsuchtsziele ausgewählt. Maße: inkl. Kopfklappe ca. 58 x 36 cm. W Werbedruck. Fläche: 350 x 40 mm auf schwarze Kopfklappe. Preis/Stk.: ab 8 Stück 3,95 Werkzeugkosten: Siehe Serviceseiten. 163 073 ohne Druck ab 14,95 163 081 für Druck ab 14,95 2 GEO-WANDKALENDER „SEHNSUCHTSORTE“ ab14 95 STÜCKAB STÜCK-PREIS 1.DRUCKFARBE 8120,9519,65 3,95 20 18,95 3,25 50 18,45 2,65 100 16,45 1,95 200 14,95 1,45 Druckkosten weitere Farben: siehe Onlineshop 1 GEO-WANDKALENDER „MEERBLICK“ ab14 95
















































4 „OLDTIMER“WANDKALENDER Faszinierende Fotoaufnahmen der schönsten Oltimer. Maße: 24 x 37,5 cm O Offsetdruck. Fläche: 225 x 35 mm Preis/Stk.: ab 50 Stück 1,10 Werkzeugkosten: Siehe Serviceseiten. 271 756 ohne Druck ab 1,49 271 748 für Druck ab 1,49 4 „OLDTIMER“WANDKALENDER ab 1 49 60 218„OLDTIMER“KALENDER554 249.-WERBETIPP* 233KALENDER | 3 „TRAUMWEGE“WANDKALENDER ab 0 99 3 „TRAUMWEGE“WANDKALENDER Schöne Zitate über Wege und Ziele. Maße: 23,5 x 33,5 cm O Offsetdruck. Fläche: 220 x 40 mm Preis/Stk.: ab 50 Stück 1,10 Werkzeugkosten: Siehe Serviceseiten. 112 491 ohne Druck ab -,99 112 506 für Druck ab -,99 1 WANDKALENDER „LANDLAUNE“ Zelebrieren Sie das Leben auf dem Land. Inspirierende Zitate von namhaften Denkern und Philosophen bringen uns eine frische Sicht auf die Natur und das Leben. 12 Monatsblätter mit Feiertagen. Maße: 24 x 37,5 cm O Offsetdruck. Fläche: 225 x 35 mm Preis/Stk.: ab 50 Stück 1,10 Werkzeugkosten: Siehe Serviceseiten. 125 342 ohne Druck ab 1,19 125 359 für Druck ab 1,19 1 „LANDLAUNE“WANDKALENDER ab1 19 2 „TRAUMSTRÄNDE“WANDKALENDER ab 1 19 2 „TRAUMSTRÄNDE“WANDKALENDER Die schönsten Urlaubsgebiete unserer Erde laden zum Träumen ein! Maße: 23,5 x 33,5 cm O Offsetdruck. Fläche: 220 x 40 mm Preis/Stk.: ab 50 Stück 1,10 Werkzeugkosten: Siehe Serviceseiten. 102 666 ohne Druck ab 1,19 102 674 für Druck ab 1,19 STÜCKAB STÜCK-PREIS 1.DRUCKFARBE 1 1,99 50 1,89 1,10 80 1,79 -,80 250 1,69 -,60 500 1,59 -,55 1.000 1,39 -,50 2.500 1,29 -,40 5.000 1,19 -,35 Druckkosten weitere Farben: siehe Onlineshop STÜCKAB STÜCK-PREIS 1.DRUCKFARBE 1 1,85 50 1,75 1,10 80 1,55 -,80 250 1,45 -,60 500 1,30 -,55 1.000 1,19 -,50 2.500 1,09 -,40 5.000 -,99 -,35 Druckkosten weitere Farben: siehe Onlineshop STÜCKAB STÜCK-PREIS 1.DRUCKFARBE 1 2,75 50 2,65 1,10 80 2,45 -,80 250 2,35 -,60 500 2,15 -,55 1.000 1,95 -,50 2.500 1,65 -,40 5.000 1,49 -,35 Druckkosten weitere Farben: siehe Onlineshop STÜCKAB STÜCK-PREIS 1.DRUCKFARBE 1 1,99 50 1,89 1,10 80 1,79 -,80 250 1,69 -,60 500 1,59 -,55 1.000 1,39 -,50 2.500 1,29 -,40 5.000 1,19 -,35 Druckkosten weitere Farben: siehe Onlineshop * Komplettpreis inklusiv einfarbigem, einseitigen Werbeaufdruck in Standardschrift











































1 WANDKALENDER „DEUTSCHLAND“ Die schönsten Städte und Landschaften Deutschlands. Maße: 24 x 37,5 cm O Offsetdruck. Fläche: 225 x 35 mm Preis/Stk.: ab 80 Stück -,70 Werkzeugkosten: Siehe Serviceseiten. 040 475 ohne Druck ab -,89 011 668 für Druck ab -,89 1 „DEUTSCHLAND“WANDKALENDER ab 0 89 Lieferung nur für den gewerblichen Bedarf. Alle Preise zzgl. MwSt.234 | KALENDER 3 „ZAUBERHAFTEKALENDER BLÜTEN“ ab 1 49 3 „ZAUBERHAFTEKALENDER BLÜTEN“ Ein fotografischer Streifzug durch den Blumengarten. Maße: 24 x 37,5 cm O Offsetdruck. Fläche: 225 x 35 mm Preis/Stk.: ab 50 Stück 1,10 Werkzeugkosten: Siehe Serviceseiten. 038 402 ohne Druck ab 1,49 040 491 für Druck ab 1,49 STÜCKAB STÜCK-PREIS 1.DRUCKFARBE 1 1,95 80 1,60 -,70 250 1,50 -,60 500 1,35 -,55 1.000 1,20 -,50 2.500 -,99 -,40 5.000 -,89 -,35 Druckkosten weitere Farben: siehe Onlineshop PREISTABELLE FÜR POS. 1 und 2 4 BILDKALENDER „EUROPA“ 12 beeindruckende Motive aus Europas Städten in hervorragender Druckqualität. Maße: 24 x 37,5 cm O Offsetdruck. Fläche: 225 x 35 mm Preis/Stk.: ab 50 Stück 1,10 Werkzeugkosten: Siehe Serviceseiten. 208 787 ohne Druck ab 1,49 208 779 für Druck ab 1,49 2 WANDKALENDER „REISEZIELE“ Faszinierende Aufnahmen von den schönsten Plätzen unserer Erde. Maße: 24 x 37,5 cm O Offsetdruck. Fläche: 225 x 35 mm Preis/Stk.: ab 80 Stück -,70 Werkzeugkosten: Siehe Serviceseiten. 039 903 ohne Druck ab -,89 040 643 für Druck ab -,89 2 „REISEZIELE“WANDKALENDER ab 0 89 4 BILDKALENDER „EUROPA“ ab 1 49 60 043„EUROPA“KALENDER113 249.-WERBETIPP* PREISTABELLE FÜR POS. 3 und 4 STÜCKAB STÜCK-PREIS 1.DRUCKFARBE 1 2,75 50 2,65 1,10 80 2,45 -,80 250 2,35 -,60 500 2,15 -,55 1.000 1,95 -,50 2.500 1,65 -,40 5.000 1,49 -,35 Druckkosten weitere Farben: siehe Onlineshop

































































235KALENDER | 1 SCHUTZENGELFAMILIENTIMER 2023 ab 1 59 2 TERMINPLANERFAMILIENab 0 99 1 FAMILIENTIMERSCHUTZENGEL 2023 12 farbenfrohe Zeichnungen von Petra Lefin mit lustigen Darstellungen kleiner Schutzengel. Dazu auf jedem viel Platz für tägliche Einträge, insgesamt 5 Spalten verfügbar. Maße: 24 x 37,5 cm O Offsetdruck. Fläche: 225 x 35 mm Preis/Stk.: ab 60 Stück -,80 Werkzeugkosten: Siehe Serviceseiten. 102 596 ohne Druck ab 1,59 102 615 für Druck ab 1,59 2 FAMILIEN-TERMINPLANER Witzig und praktischer zugleich. Jedes Blatt ist mit einem Cartoon aus ganz alltäglichen Lebenssituationen versehen. Mit viel Platz für Eintragungen. Maße: 24 x 37,5 cm O Offsetdruck. Fläche: 225 x 35 mm Preis/Stk.: ab 80 Stück -,70 Werkzeugkosten: Siehe Serviceseiten. 208 051 ohne Druck ab -,99 208 043 für Druck ab -,99 STÜCKAB STÜCK-PREIS 1.DRUCKFARBE 1 1,95 80 1,79 -,70 250 1,69 -,60 500 1,49 -,55 1.000 1,39 -,50 2.500 1,19 -,40 5.000 -,99 -,35 Druckkosten weitere Farben: siehe Onlineshop STÜCKAB STÜCK-PREIS 1.DRUCKFARBE 1 2,49 60 2,39 -,80 250 2,29 -,60 500 2,09 -,55 1.000 1,99 -,50 2.500 1,79 -,40 5.000 1,59 -,35 Druckkosten weitere Farben: siehe Onlineshop 4 100-JÄHRIGER WANDKALENDER Ein reicher Schatz an Bauernregeln begleitet Sie in unserem 100-jährigen Kalender durch das Jahr 2023. Maße: 23,5 x 33,5 cm O Offsetdruck. Fläche: 220 x 40 mm Preis/Stk.: ab 80 Stück -,80 Werkzeugkosten: Siehe Serviceseiten. 125 203 ohne Druck ab -,99 125 211 für Druck ab -,99 4 100-JÄHRIGERWANDKALENDER ab 0 99 3
Gesundes Wachstum vorprogrammiert: Mit den wertvollen Gartentipps von Günther ziehen Sie Ihre Gartenpflanzen groß und kräftig. Mit Platz für eigene Anmerkungen. Maße: 24,5 x 34,5 cm O Offsetdruck. Fläche: 220 x 40 mm Preis/Stk.: ab 80 Stück -,80 Werkzeugkosten: Siehe Serviceseiten. 389 ohne Druck
ab -,99 173 397 für Druck ab -,99 3 „GÜNTHER‘SWANDKALENDER GARTENPLANER“ ab 0 99 STÜCKAB STÜCK-PREIS 1.DRUCKFARBE 1 1,95 80 1,75 -,80 250 1,60 -,60 500 1,45 -,55 1.000 1,25 -,50 2.500 1,09 -,40 5.000 -,99 -,35 Druckkosten weitere Farben: siehe Onlineshop STÜCKAB STÜCK-PREIS 1.DRUCKFARBE 1 1,95 80 1,75 -,80 250 1,60 -,60 500 1,45 -,55 1.000 1,25 -,50 2.500 1,09 -,40 5.000 -,99 -,35 Druckkosten weitere Farben: siehe Onlineshop * Komplettpreis inklusiv einfarbigem, einseitigen Werbeaufdruck in Standardschrift
„GÜNTHER‘SWANDKALENDERGARTENPLANER“
173







































































102 561 für Druck ab
Lieferung nur für den gewerblichen Bedarf. Alle Preise zzgl. MwSt. 3 „TIERISCHWANDKALENDERCOOL“ Fantastische Tierbilder gepaart mit frechen Sprüchen. Auf der Rückseite runden Jahresübersichten von 2023 und 2024, Ferientermine sowie ein 100-jähriger Kalender den praktischen Nutzen ab. Maße: 23,5 x 33,5 cm O Offsetdruck. Fläche: 220 x 40 mm Preis/Stk.: ab 80 Stück -,80 Werkzeugkosten: Siehe Serviceseiten. 125 182 ohne Druck ab -,99 125 199 für Druck ab -,99
Die treuesten
Maße:
2 WANDKALENDER „HUNDE“ Begleiter des Menschen, Tag Tag. 23,5 x 33,5 220 x 40 100 Stück -,80 -,89 -,89 -,80
236 | KALENDER
STÜCKAB STÜCK-PREIS 1.DRUCKFARBE 1 1,95 100 1,55
250 1,45 -,60 500 1,30 -,55 1.000 1,19 -,50 2.500 1,09 -,40 5.000 -,89 -,35 Druckkosten weitere Farben: siehe Onlineshop PREISTABELLE FÜR POS. 1 und 2 STÜCKAB STÜCK-PREIS 1.DRUCKFARBE 1 2,09 80 1,89 -,80 250 1,79 -,60 500 1,59 -,55 1.000 1,39 -,50 2.500 1,19 -,40 5.000 -,99 -,35 Druckkosten weitere Farben: siehe Onlineshop STÜCKAB STÜCK-PREIS 1.DRUCKFARBE 1 1,79 80 1,55 -,80 250 1,45 -,60 500 1,30 -,55 1.000 1,19 -,50 2.500 -,99 -,40 5.000 -,89 -,35 Druckkosten weitere Farben: siehe Onlineshop 3 „TIERISCHWANDKALENDERCOOL“ ab 0 99 1 „KATZEN“WANDKALENDER ab 0 89 2 „HUNDE“WANDKALENDER ab 0 89 4 „BLICKWANDKALENDERINSTIERREICH“ ab 0 89 4 „BLICKWANDKALENDERINSTIERREICH“ Faszinierende Welt wildlebender Tiere. Maße: 24 x 37,5 cm O Offsetdruck. Fläche: 225 x 35 mm Preis/Stk.: ab 80 Stück -,80 Werkzeugkosten: Siehe Serviceseiten. 043 902 ohne Druck ab -,89 040 434 für Druck ab -,89
für
cm O Offsetdruck. Fläche:
1 WANDKALENDER „KATZEN“ Süße Katzenbabys verzaubern Ihre Umgebung. Maße: 23,5 x 33,5 cm O Offsetdruck. Fläche: 220 x 40 mm Preis/Stk.: ab 100 Stück -,80 Werkzeugkosten: Siehe Serviceseiten. 102 537 ohne Druck ab -,89 102 545 für Druck ab -,89
mm Preis/Stk.: ab
Werkzeugkosten: Siehe Serviceseiten. 102 553 ohne Druck ab






















































Die
2 BAUERNKALENDERWANDKALENDER ab 5 95 3 TISCHKALENDER ab 0 99 237KALENDER | 1 „MOTIVATION“WANDKALENDER Mit 12 Kalenderblättern zur Mitarbeitermotivation. Pro Seite einzeiliges Monats-Kalendarium mit farbig markierten Sonn- und Feiertagen. Maße: 30 x 42 cm W Werbedruck. Fläche: 280 x 40 mm Preis/Stk.: ab 30 Stück 1,65 Werkzeugkosten: Siehe Serviceseiten. 208 094 ohne Druck ab 3,95 208 086 für Druck ab 3,95 1 „MOTIVATION“WANDKALENDER ab 3 95 2 BAUERNKALENDERWANDKALENDER
kunstvollen Zeichnungen mit Vignetten zeigen 12 romantische Szenen aus dem Landleben. Maße: 30,5 x 42,6 cm W Werbedruck. Fläche: 280 x 35 mm Preis/Stk.: ab 20 Stück 1,70 Werkzeugkosten: Siehe Serviceseiten. 093 209 ohne Druck ab 5,95 029 287 für Druck ab 5,95 STÜCKAB STÜCK-PREIS 1.DRUCKFARBE 2018,257,95 1,70 75 7,65 1,20 150 7,25 1,10 250 6,95 -,90 500 5,95 -,65 Druckkosten weitere Farben: siehe Onlineshop 3 TISCHKALENDER Natur pur! Zauberhafte Tischkalender mit Monatsübersicht, Feiertage (D, A, CH), Mondphasen, sowie auf der Rückseite ein 100-jähriger Kalender. Die Ausführungen „Blumen“, „Meine Tiere“ und „Landschaften“ haben zusätzlich jeweils 12 Postkarten aus 100% nachhaltigem Papier zum Heraustrennen. Maße: 20 x 16,8 cm W Werbedruck. Fläche: 160 x 15 mm Preis/Stk.: ab 100 Stück -,50 Werkzeugkosten: Siehe Serviceseiten. 142 633 Blumen ab -,99 142 641 Meine Tiere ab -,99 142 650 Landschaften ab -,99 142 668 Momente ab -,99 STÜCKAB STÜCK-PREIS 1.DRUCKFARBE 10011,551,45 -,50 250 1,29 -,45 500 1,19 -,35 1.000 1,09 -,30 2.500 -,99 -,25 Druckkosten weitere Farben: siehe Onlineshop STÜCKAB STÜCK-PREIS 1.DRUCKFARBE 1 5,95 30 5,65 1,65 50 5,45 1,55 100 4,95 1,45 250 4,75 -,85 500 4,45 -,65 1.000 3,95 -,45 Druckkosten weitere Farben: siehe Onlineshop






















































































































25 043„ERFOLGSWEGE“WANDKALENDER839 199.-WERBETIPP* Lieferung nur für den gewerblichen Bedarf. Alle Preise zzgl. MwSt.238 | KALENDER 1 „MOTIVATION“3-MONATS-WANDKALENDER 12 Kalenderblätter mit Sprüchen zur Mitarbeitermotivation. Dazu ein 3-Monatskalendarium mit Datumsschieber. 4-sprachiges Kalendarium. Schwarze Kopfklappe. Maße: aufgeklappt 30 x 74 cm W Fläche:Werbedruck. ca. 270 x 35 mm Preis/Stk.: ab 30 Stück 1,65 Werkzeugkosten: Siehe Serviceseiten. 282 699 ohne Druck ab 3,75 282 682 für Druck ab 3,75 1 3-MONATS„MOTIVATION“WANDKALENDER ab 3 75 STÜCKAB STÜCK-PREIS 1.DRUCKFARBE 3015,254,75 1,65 100 4,35 1,45 250 4,15 -,85 500 3,95 -,65 1.000 3,75 -,45 Druckkosten weitere Farben: siehe Onlineshop 2 „ERFOLGSWEGE“WANDKALENDER 12 Kalenderblätter mit genialen Leitsätzen zur optimalen Kundenbetreuung mit eindrucksvollen Motiven aus aller Welt. Maße: 30,5 x 42,6 cm W Fläche:Werbedruck. 280 x 35 mm Preis/Stk.: ab 25 Stück 1,20 Werkzeugkosten: Siehe Serviceseiten. 091 598 ohne Druck ab 3,75 091 580 für Druck ab 3,75 2 „ERFOLGSWEGE“WANDKALENDER ab 3 75 STÜCKAB STÜCK-PREIS 1.DRUCKFARBE 1 5,95 25 5,75 1,20 50 5,45 1,10 100 4,95 -,90 250 4,45 -,70 500 3,95 -,60 1.000 3,75 -,50 Druckkosten weitere Farben: siehe Onlineshop























2 „BERGWELTEN“WANDKALENDER Von den Anden zu den Alpen, 12 imposante Massive versprühen frischen Wind. Mit übersichtlichem Kalendarium und Platz für Eintragungen. Maße: 24 x 37,5 cm O Offsetdruck. Fläche: 225 x 35 mm Preis/Stk.: ab 80 Stück -,80 Werkzeugkosten: Siehe Serviceseiten. 173 305 ohne Druck ab -,99 173 313 für Druck ab -,99 STÜCKAB STÜCK-PREIS 1.DRUCKFARBE 1 2,09 80 1,89 -,80 250 1,69 -,60 500 1,49 -,55 1.000 1,29 -,50 2.500 1,09 -,40 5.000 -,99 -,35 Druckkosten weitere Farben: siehe Onlineshop 2 „BERGWELTEN“WANDKALENDER ab 0 99 3 DER„ERLEBNISWELTWANDKALENDERDÜFTE“ ab 2 95 Riechen Sie mal!Es duftet! 1 WANDKALENDER „MOND“ Praktischer Tagesplaner im Zeichen des Mondes. Übersichtlich aufgebaut zeigt dieser Kalender die Einflüsse des Erdtrabanten in allen wichtigen Lebensbereichen wie z.B. Pflanzen, Körper, Haushalt etc.. Maße: 23,5 x 33,5 cm O Offsetdruck. Fläche: 220 x 40 mm Preis/Stk.: ab 80 Stück -,80 Werkzeugkosten: Siehe Serviceseiten. 015 407 ohne Druck ab 1,15 015 466 für Druck ab 1,15 STÜCKAB STÜCK-PREIS 1.DRUCKFARBE 1 1,89 80 1,69 -,80 250 1,55 -,60 500 1,45 -,45 1.000 1,35 -,42 2.500 1,25 -,40 5.000 1,15 -,35 Druckkosten weitere Farben: siehe Onlineshop 1 WANDKALENDER „ MOND“ ab 1 15 239KALENDER | 3 „ERLEBNISWELTWANDKALENDERDER DÜFTE“ Riechen Sie mal! Einfach mit dem Finger über die Kalenderblätter reiben und schon entfalten sich 12 verschiedene Düfte, den Jahreszeiten angepasst. Maße: 24,5 x 34,5 cm O Offsetdruck. Fläche: 220 x 40 mm Preis/Stk.: ab 50 Stück -,80 Werkzeugkosten: Siehe Serviceseiten. 286 838 ohne Druck ab 2,95 286 846 für Druck ab 2,95 STÜCKAB STÜCK-PREIS 1.DRUCKFARBE 5014,254,10 -,80 100 3,95 -,60 250 3,45 -,40 500 3,25 -,30 1.000 2,95 -,25 Druckkosten weitere Farben: siehe Onlineshop * Komplettpreis inklusiv einfarbigem, einseitigen Werbeaufdruck in Standardschrift










































240 | KALENDER 4 „KARLSSTREIFENKALENDERGARTENPLANER“
Lieferung nur für den gewerblichen Bedarf. Alle Preise zzgl. MwSt. Wertvolle Tipps rund um das Thema Garten. Mit farbenfrohen Gartenbildern. Maße: 11 x 50 cm W Werbedruck. Fläche: 100 x 40 mm Preis/Stk.: ab 50 Stück -,65 Werkzeugkosten: Siehe Serviceseiten. 211 014 ohne Druck ab 1,99 282 800 für Druck Bauernregel und detailvolle Illustrationen wie „anno dazumal“ spiegeln das Leben auf dem Land im Laufe der Monaten wider. Maße: 11 x 50 cm W Werbedruck. Fläche: 100 x 40 mm Preis/Stk.: ab 50 Stück -,65 Werkzeugkosten: Siehe Serviceseiten 210 999 ohne Druck ab 2,95 136 243 für Druck diesen Kräutern und Gewürzen verpassen Sie Ihren Speisen eine Aromatherapie. Auf den Monatsrückseiten finden Sie Erläuterungen zu den gezeigten Bildern sowie Rezeptvorschläge. Maße: 11 x 50 cm W Werbedruck. Fläche: 100 x 40 mm Preis/Stk.: ab 120 Stück -,55 Werkzeugkosten: Siehe Serviceseiten. 211 039 ohne Druck ab -,79 102 490 für Druck
ab 1,99 2 BAUERN-STREIFENKALENDER
ab 2,95 1 „AROMAKÜCHE“STREIFENKALENDER Mit
ab -,79 3 KÄTHES KÜCHENPLANER Nostalgischer Monatskalender mit 13 Blättern. Rückseiten mit Themen wie z. B. Horoskope, Haushalts- und Gesundheitstipps. Maße: 11 x 50 cm W Werbedruck. Fläche: 100 x 40 mm Preis/Stk.: ab 50 Stück -,65 Werkzeugkosten: Siehe Serviceseiten. 211 241 ohne Druck ab 1,95 033 214 für Druck ab 1,95 2 BAUERNKALENDER ab 2 95 3 KÄTHES KÜCHENPLANER ab 1 95 4 „KARLSSTREIFENKALENDER GARTENPLANER“ ab 1 99 STÜCKAB STÜCK-PREIS 1.DRUCKFARBE 12011,291,19 -,55 250 1,09 -,45 1.000 -,99 -,40 2.000 -,89 -,35 3.000-,79 -,25 Druckkosten weitere Farben: siehe Onlineshop STÜCKAB STÜCK-PREIS 1.DRUCKFARBE 5013,453,25 -,65 150 2,95 -,55 300 2,75 -,40 600 2,55 -,35 1.500 2,35 -,25 2.500 2,19 -,20 7.500 1,99 -,18 Druckkosten weitere Farben: siehe Onlineshop STÜCKAB STÜCK-PREIS 1.DRUCKFARBE 5013,953,55 -,65 150 3,35 -,55 300 3,25 -,40 1.000 3,15 -,30 2.000 2,95 -,25 Druckkosten weitere Farben: siehe Onlineshop STÜCKAB STÜCK-PREIS 1.DRUCKFARBE 5013,152,95 -,65 150 2,80 -,55 300 2,65 -,40 600 2,25 -,35 1.500 1,95 -,25 Druckkosten weitere Farben: siehe Onlineshop 1 „AROMAKÜCHE“STREIFENKALENDER ab 0 79

































































KLASSIKER STREIFENKALENDER DRUCK4C 241KALENDER | STÜCKAB STÜCK-PREIS DIGITAL4C 1 150-,-,9085 -,55 500-,79 -,50 1.000-,75 -,40 2.500-,69 -,35 5.000-,59 -,30 STÜCKAB STÜCK-PREIS 1.DRUCKFARBE 5012,952,85 -,65 150 2,75 -,50 500 2,55 -,40 1.500 2,25 -,30 2.500 1,95 -,20 Druckkosten weitere Farben: siehe Onlineshop STÜCKAB STÜCK-PREIS 1.DRUCKFARBE 6012,652,45 -,55 150 2,25 -,50 500 1,95 -,40 1.500 1,79 -,30 Druckkosten weitere Farben: siehe Onlineshop 3 STREIFEN-WANDKALENDER 13 Kalenderblätter inkl. Deckblatt, 2-farbig bedruckt. Mit Angaben von Monat, Kalenderwoche und Wochentag. Maße: 12 x 50 cm D Digitaldruck 4c. Fläche: 100 x 75 mm Preis/Stk.: ab 150 Stück -,55 Werkzeugkosten: einmalig 55,051 707 ohne Druck ab -,59 011 908 für Druck ab -,59 1 HAPPY-NOTIZKALENDER 12 Blätter mit lustigen Illustrationen. Maße: 11,3 x 49,5 cm W Werbedruck. Fläche: 100 x 40 mm Preis/Stk.: ab 50 Stück -,65 Werkzeugkosten: Siehe Serviceseiten. 032 129 ab 1,95 2 „MITSTREIFENKALENDERDEMMONDIMEINKLANG“ Auf 12 farbigen Monatsblättern werden die Mondphasen und Tierkreiszeichen abgebildet. Symbolen informieren über den Einfluss des Mondes auf Mensch und Natur. Inkl. Ratschläge für die individuelle Planung an bestimmten Tagen. Maße: ca. 11 x 50 cm W Werbedruck. Fläche: 100 x 40 mm Preis/Stk.: ab 60 Stück -,55 Werkzeugkosten: Siehe Serviceseiten. 210 966 ohne Druck ab 1,79 041 175 für Druck ab 1,79 1 HAPPYNOTIZKALENDER ab 1 952 EINKLANG“„MITSTREIFENKALENDERDEMMONDIM ab 1 79 3 STREIFENWANDKALENDER ab 0 59 * Komplettpreis inklusiv einfarbigem, einseitigen Werbeaufdruck in Standardschrift 200 218WANDKALENDERSTREIFEN-587 329.-WERBETIPP*








































Praktisch: die niedlichen Wesen können als Postkarte ausgeschnitten werden. Maße: 12 x 38 cm W Werbedruck. Fläche: 100 x 40 mm Preis/Stk.: ab 100 Stück -,50 Werkzeugkosten: Siehe Serviceseiten. 211 006 ohne Druck ab -,89 136 405 für Druck ab -,89
„SCHÖNEPOSTKARTENKALENDERMOMENTE“
Mit 12 tollen Naturaufnahmen. Mit Platz für Notizen. Maße: ca. 12 x 38 cm W Werbedruck. Fläche: 100 x 40 mm Preis/Stk.: ab 100 Stück -,50 Werkzeugkosten: Siehe Serviceseiten. 210 982 ohne Druck ab -,89 057 408 für Druck ab -,89
Kalendarium. Dazu auf den Monatsrückseiten Tips und Anregungen zu einem ausgeglichenen Leben. Maße: 13 x 53,5 cm W Werbedruck. Fläche: 100 x 40 mm Preis/Stk.: ab 100 Stück -,50 Werkzeugkosten: Siehe Serviceseiten. 211 047 ohne Druck ab -,89 163 112 für Druck ab -,89 4 POSTKARTENKALENDER „NAIVE MALEREI“ ab 0 89 3 STREIFEN„AUSZEIT“KALENDER ab 0 89 2 POSTKARTEN„SCHÖNEKALENDERMOMENTE“ ab 0 89 1 POSTKARTEN„TIERKINDER“KALENDER ab 0 89
STÜCKAB STÜCK-PREIS 1.DRUCKFARBE 1 1,65 100 1,55 -,50 250 1,39 -,45 1.000 1,19 -,40 2.000 -,99 -,35 3.000 -,89 -,25 Druckkosten weitere Farben: siehe Onlineshop PREISTABELLE FÜR POS. 1, 2, 3 und 4 100 „NaivePOSTKARTENKALENDERMalerei“274035 229.-WERBETIPP* Lieferung nur für den gewerblichen Bedarf. Alle Preise zzgl. MwSt.242 | KALENDER 4 „NAIVEPOSTKARTENKALENDERMALEREI“ 12 Kunstpostkarten mit schönen Motiven zu allen Jahreszeiten. Zusätzlich mit viel Platz für Eintragungen. Maße: ca. 12 x 38 cm W Werbedruck. Fläche: 100 x 40 mm Preis/Stk.: ab 100 Stück -,50 Werkzeugkosten: Siehe Serviceseiten. 210 974 ohne Druck ab -,89 057 393 für Druck ab -,89 1 „TIERKINDER“POSTKARTENKALENDER
2
3 STREIFENKALENDER „AUSZEIT“ Wohltuende Anblicke auf einem übersichtlichen










































DER FREIENKREATIVITÄTLAUFLASSEN! INDIVIDUELL GESTALTBAR. DRUCK4C faltbarWire-Odurch MADE GERMANYIN 243KALENDER | 1 3-MONATS-KALENDER „FOLD 3“ MIT WIRE-O-BINDUNG Zusammenfaltbarer 3-Monats-Kalender mit internationalen Feiertagen und deutscher Ferienübersicht. Individueller Werbedruck auf Kopfleiste und Zwischen-, sowie Fußleiste. Kalenderblock: 80g/m2, Wire-O-Bindung mit weißem Draht. Maße: 34 x 78,7 cm D Digitaldruck. Fläche: Kopflasche 340 x 177 mm, 1. Zwischenleiste 340 x 38 mm, weitere Zwischenleisten und Fußleiste je 340 x 43 mm. Preis/Stk.: ab 50 Stück 2,45 Werkzeugkosten: Siehe Serviceseiten. 223 873 ohne Druck ab 3,15 223 881 für Druck ab 3,15 2 4-MONATS-KALENDER „FOLD 4“ MIT WIRE-O-BINDUNG Faltbarer 4-Monats-Kalender. Merkmale wie Pos. 1 Maße: 34 x 99,2 cm D Digitaldruck. Fläche: Kopfl asche 340 x 177 mm, 1. Zwischenleiste 340 x 38 mm, weitere Zwischenleisten und Fußleiste je 340 x 43 Preis/Stk.:mm. ab 50 Stück 2,45 Werkzeugkosten: Siehe Serviceseiten. 223 890 ohne Druck ab 4,45 223 904 für Druck ab 4,45 STÜCKAB STÜCK-PREIS DRUCK4C 1 4,95 50 4,45 2,45 100 4,25 1,95 200 4,05 1,75 300 3,95 1,45 500 3,55 1,25 1.000 3,15 -,99 1 3-MONATS-KALENDER„FOLD3“ ab 3 15 2 4-MONATSKALENDER „FOLD 4“ ab 4 45 NEU STÜCKAB STÜCK-PREIS DRUCK4C 1 6,95 50 5,95 2,45 100 5,55 1,95 200 5,35 1,75 300 5,15 1,45 500 4,95 1,25 1.000 4,45 -,99 * Komplettpreis inklusiv einfarbigem, einseitigen Werbeaufdruck in Standardschrift







1 3-MONATS-KALENDER RECYCLING BUDGET 3 ab 0 85 1 RECYCLING3-MONATS-KALENDERBUDGET3 Besonders preiswertes Modell mit moderner Typografie auf Recyclingpapier (hergestellt aus 100% Altpapier und ausgezeichnet mit dem Umweltzeichen „Blauer Engel“) mit „90er ISO-Weiße“. Mit praktischem Datumschieber, Kalendarium 3-sprachig. Maße: Mit Kopfklappe, 30 x 49 cm Kalender, 30 x 35 cm D Digitaldruck 4c. Fläche: 300 x 150 mm Preis/Stk.: ab 100 Stück -,70 Werkzeugkosten: Siehe Serviceseiten. 192 621 ohne Druck ab -,85 192 630 für Druck ab -,85 STÜCKAB STÜCK-PREIS DRUCK4C 1 1,65 100 1,35 -,70 250 1,25 -,60 500 1,15 -,40 1.000 -,99 -,35 2.500 -,90 -,30 5.000 -,85 -,25 2 4-MONATS-KALENDER RECYCLING BUDGET 4 ab 1 25 2 RECYCLING4-MONATS-KALENDERBUDGET4 Merkmale wie Pos. 1 Maße: Mit Kopfklappe, 30 x 60 cm Kalender, 30 x 42 cm D Digitaldruck 4c. Fläche: 300 x 150 mm Preis/Stk.: ab 50 Stück -,95 Werkzeugkosten: Siehe Serviceseiten. 192 648 ohne Druck ab 1,25 192 656 für Druck ab 1,25 STÜCKAB STÜCK-PREIS DRUCK4C 1 2,30 50 2,05 -,95 100 1,85 -,70 250 1,75 -,60 500 1,65 -,40 1.000 1,45 -,35 2.500 1,35 -,30 5.000 1,25 -,25 DRUCK4C DRUCK4C ÖKOLOGISCH UND NACHHALTIG AUS RECYCLINGPAPIER MIT DEM BLAUEN ENGEL Seit 40 Jahren garantiert das Umweltzeichen Blauer Engel hohe Standards zum Schutz unserer Umwelt. Unabhängig und glaubwürdig setzt der Blaue Engel anspruchsvolle Maßstäbe für umweltfreundliche Produkte. Die Kriterien werden kontinuierlich geprüft und weiterentwickelt. Recycling-Papier ist ein reiner Sekundärrohstoff und somit der konsequente Weg der Nachhaltigkeit. 1 3-MONATSRECYCLINGKALENDER BUDGET 3 ab 0 85 MADE GERMANYIN Lieferung nur für den gewerblichen Bedarf. Alle Preise zzgl. MwSt.244 | KALENDER







































2 WANDPLANER RECYCLINGPAPIERHORIZONT 98 x 66 cm inkl. 4C Druck Jahresübersichtskalender im Großformat. Deutsch 1sprachig 14 Monate: Dez. 2022 - Jan. 2024. Material: Recyclingpapier - hergestellt aus 100% Altpapier mit dem Umweltzeichen Blauer Engel Maße: ca. 98 x 66 cm. D Digitaldruck 4c. Fläche: auf Kopfteil 800 x 80 mm Preis/Stk.: siehe Tabelle Werkzeugkosten: Siehe Serviceseiten. 211 811 inkl. 4C Druck ab 1,29 STÜCKAB STÜCKPREISINKL.4C 100 5,95 200 3,25 400 2,19 750 1,59 1.000 1,29 1 3-MONATSBLOCKKALENDER PROFIL 3 RECYCLING ab 2 45 1 PROFIL4-MONATSBLOCKKALENDERPROFIL3-MONATSBLOCKKALENDER3RECYCLING/4RECYCLING/inkl.4CDruck Umweltfreundlich & individuell gestaltbarer Monatsblockkalender. 4sprachig D/GB/F/E, hellgraue Kalenderblocks einzeln perforiert, Portooptimiert zu versenden: Rückwand zum dreimaligen Falten gerillt, Blockhalter-Stanzung, Aufhängeöse aus Metall, Datumsschieber rot. Material Recyclingpapier - hergestellt aus 100% Altpapier mit dem Umweltzeichen Blauer Engel M aße: 3-Monatskalender: 33 x 70 cm, 4-Monatskalender: 33 x 90 cm D Digitaldruck 4c. Fläche: auf die komplette Rückwand 330 x 700 mm, 330 x 900 mm Preis/Stk.: siehe Tabelle Werkzeugkosten: Siehe Serviceseiten. 211 820 3-Monate ab 2,45 211 838 4-Monate ab 2,95 DRUCK4CABSTÜCK STÜCKPREIS3MONATEINKL.4C STÜCKPREIS4MONATEINKL.4C 25 9,50 10,50 50 6,25 7,25 100 4,50 5,25 200 3,95 4,50 500 2,85 3,50 1.000 2,45 2,95 2 WANDPLANER RECYCLINGPAPIERHORIZONT ab 1 29 1 4-MONATSBLOCKKALENDER PROFIL 4 RECYCLING ab 2 95 DRUCK4C MADE GERMANYIN 245KALENDER | MADE GERMANYIN


















































Lieferung nur für den gewerblichen Bedarf. Alle Preise zzgl. MwSt.
246 | KALENDER
3 4-MONATS-BLOCKKALENDER JUNIOR 4 4-Monatskalender mit einzeln abreißbaren Monatsblättern, praktisch zusammenfaltbar. Die komplette Rückwand ist bedruckbar. Maße: inkl. Kopfklappe, ca. 33 x 87,5 cm W Werbedruck. Fläche: auf Rückwand, Kopflasche 330 x 175 mm, Zwischenleisten und Fußleiste je 330 x 27 mm. Wir bitten um Angabe der genauen Druckstände für Ihre gewünschte Werbeanbringung Preis/Stk.: ab 50 Stück für erste Farbe 1,95 jede weitere Druckfarbe -,85 Werkzeugkosten: Siehe Serviceseiten. 102 779 ohne Druck ab 2,15 102 787 für Druck ab 2,15
2 3-MONATS-BLOCKKALENDER JUNIOR 3 3-Monatskalender mit einzeln abreißbaren Monatsblättern, praktisch zusammenfaltbar.
Die Besonderheit dieses Kalenders liegt darin, dass die komplette Rückwand bedruckbar ist. Maße: inkl. Kopfklappe, ca. 33 x 70 cm W Werbedruck. Fläche: auf Rückwand, Kopfl asche 330 x 175 mm, Zwischenleisten und Fußleiste je 330 x 27 mm. Wir bitten um Angabe der genauen Druckstände für Ihre gewünschte Werbeanbringung Preis/Stk.: ab 50 Stück für die erste Farbe 1,95 jede weitere Druckfarbe -,85 Werkzeugkosten: Siehe Serviceseiten. 091 776 ohne Druck ab 1,89 102 762 für Druck ab 1,89 2 KALENDER3-MONATS-BLOCK-JUNIOR 3 ab 1 89 3 KALENDER4-MONATS-BLOCK-JUNIOR 4 ab 2 15 STÜCKAB STÜCK-PREIS 1.DRUCKFARBE WEITEREFARBE 1 2,95 50 2,75 1,95 -,85 100 2,55 1,15 -,75 200 2,35 -,90 -,50 500 2,15 -,85 -,35 1.000 1,89 -,75 -,30 1 4-MONATS-WANDKALENDER Für alle Kunden, die längerfristig in die Zukunft planen. Roter Druck der Sonn- und Feiertage. Rotes Datumsichtfenster für optimalen Überblick. Kalender dreisprachig: deutsch, englisch, französisch. Maße Kalender: 30 x 60 cm, Kalendarium: 30 x 46 cm. O Offsetdruck. Fläche: 280 x 100 mm Preis/Stk.: ab 80 Stück -,65 Werkzeugkosten: Siehe Serviceseiten. D Digitaldruck 4c. Fläche: 285 x 100 mm Preis/Stk.: ab 80 Stück 1,20 Einmalige Werkzeugkosten 55,208 762 ohne Druck ab 1,39 208 754 für Druck ab 1,39 STÜCKAB STÜCK-PREIS DRUCK1C DIGITAL4C 1 1,99 80 1,75 -,65 1,20 200 1,69 -,55 1,05 500 1,64 -,45 -,95 1.000 1,49 -,35 -,72 2.500 1,39 -,30 -,62 1 WAND-4-MONATS KALENDER ab 1 39 STÜCKAB STÜCK-PREIS 1.DRUCKFARBE WEITEREFARBE 1 3,60 50 3,45 1,95 -,85 100 3,25 1,15 -,75 200 3,10 -,90 -,50 500 2,55 -,85 -,35 1.000 2,15 -,75 -,30 SPARPORTO VERSION 80 218WANDKALENDER4-MONATS-503 215.-WERBETIPP*DRUCK4C

















DRUCK4C 247KALENDER | 1 3-MONATS-WANDKALENDER Groß in der Wirkung und enorm klein im Preis. Für Planung, Einkauf, Verkauf, Versand, Buchhaltung. Mit praktischem Datumschieber. Maße: Kopfklappe, 30 x 12 cm. Kalender, 51 x 30 cm Einzelversandkarton lose beigelegt unter der Art.Nr. 029 238 gegen Aufpreis von -,60/Stk. zusätzliches Verpacken -,25/Stk. O Offsetdruck. Fläche: 280 x 100 mm Preis/Stk.: ab 150 Stück siehe Tabelle Werkzeugkosten: Siehe Serviceseiten. D Digitaldruck 4c. Fläche: 280 x 100 mm Preis/Stk.: ab 150 Stück siehe Tabelle Einmalige Werkzeugkosten 55,Für Druck: 017 280 anthrazit ab -,39 033 433 hellgrau ab -,39 033 476 blau ab -,39 208 875 hellblau ab -,39 208 939 grün ab -,39 Ohne Druck: 017 298 anthrazit ab -,39 035 603 hellgrau ab -,39 038 200 blau ab -,39 208 883 hellblau ab -,39 208 947 grün ab -,39 STÜCKAB STÜCK-PREIS DRUCK1C DIGITAL4C 1 -,75 150 -,69 -,37 -,65 500 -,62 -,35 -,60 1.000 -,56 -,33 -,55 2.500 -,52 -,31 -,50 5.000 -,44 -,29 -,45 10.000 -,39 -,26 -,40 Druckkosten weitere Farben: siehe Onlineshop 1 3-MONATS-WANDKALENDER ab 0 39 * Komplettpreis inklusiv einfarbigem, einseitigen Werbeaufdruck in Standardschrift 150 3043043KALENDERWAND-MONATS-373hellblau445grün 199.-WERBETIPP* 150 3218hellgraujeKALENDERWAND-MONATS-50anthrazit,undblau520 199.-WERBETIPP*






















80 233WANDKALENDER3-MONATS-150 279.-WERBETIPP* DRUCK4C MONATS-WANDKALENDER VORAUSSCHAUEN IST DAS REZEPT ZUM ERFOLG 150 043WANDKALENDER5-MONATS-566 279.-WERBETIPP* Lieferung nur für den gewerblichen Bedarf. Alle Preise zzgl. MwSt.248 | KALENDER 2 4-MONATS-WANDKALENDER „CONTROL“ Preisgünstiger 4-Monatskalender mit großer Werbefläche. Für alle, die gerne längerfristig in die Zukunft planen wollen. 3-sprachig (deutsch, englisch, französisch) , Datumsschieber, fertig montiert. Maße: inkl. Kopfklappe, ca. 30 x 56 cm. Kalendarium ca. 30 x 42 cm O Offsetdruck. Fläche: 280 x 100 mm Preis/Stk.: ab 100 Stück -,45 Werkzeugkosten: Siehe Serviceseiten. D Digitaldruck 4c. Fläche: 285 x 100 mm Preis/Stk.: ab 100 Stück -,95 Einmalige Werkzeugkosten 55,082 860 ohne Druck ab -,99 082 878 für Druck ab -,99 3 3-MONATS-WANDKALENDER MIT BILD Je nach Jahreszeit passende Motive auf den 12 einzelnen Kalenderblättern. Mit Angabe der JahresWoche und der Feiertage, 3-sprachig (deutsch, englisch, französisch), Datumsschieber. Maße: 30 x 60 cm W Werbedruck. Fläche: 280 x 120 mm Preis/Stk.: ab 80 Stück -,60 Werkzeugkosten: Siehe Serviceseiten. 209 005 ohne Druck ab 1,99 208 998 für Druck ab 1,99 1 5-MONATS-WANDKALENDER Dieser 5-Monatskalender ist klar und übersichtlich aufgebaut. Mit viel Raum für Ihre Werbung. 3-sprachig (deutsch, englisch, französisch), deutsche Feiertage und Datumsschieber. Maße: ca. 30 x 60 cm O Offsetdruck. Fläche: 280 x 120 mm Preis/Stk.: ab 100 Stück -,40 Werkzeugkosten: Siehe Serviceseiten. 034 102 ohne Druck ab -,95 034 080 für Druck ab -,95 2 4-MONATS „CONTROL“WANDKALENDER ab 0 99 1 5-MONATS WANDKALENDER ab 0 95 3 3-MONATS WANDKALENDER ab 1 99 STÜCKAB STÜCK-PREIS 1.DRUCKFARBE 1 1,49 100 1,30 -,40 250 1,25 -,37 500 1,09 -,35 1.000 1,05 -,30 2.500 -,95 -,25 Druckkosten weitere Farben: siehe Onlineshop STÜCKAB STÜCK-PREIS DRUCK1C DIGITAL4C 1 1,49 100 1,35 -,45 -,95 250 1,29 -,40 -,85 500 1,19 -,35 -,75 1.000 1,09 -,30 -,50 2.500 -,99 -,25 -,45 STÜCKAB STÜCK-PREIS 1.DRUCKFARBE 1 2,95 80 2,55 -,60 200 2,35 -,55 500 2,25 -,50 1.000 2,10 -,45 2.000 1,99 -,40 Druckkosten weitere Farben: siehe Onlineshop














praktische 3-Monats-Planer
Der jetzt in der Anstatt teures Porto für ein Päckchen haben Sie bei dieser Version, die sich durch eine knick- und damit faltbare Rückwand gegenüber der Standardversion unterscheidet, lediglich das Porto für einen Maxi-Brief zu zahlen, also ca. 65% Ersparnis. Der gefaltete Kalender kann in einem Standard-B4Umschlag versendet werden. M aße: Kopfklappe, ca. 30 x 12 cm. Kalendarium, ca. 51 x 30 cm O Offsetdruck. Fläche:
portooptimierten Postversion.
Porto sparen mit Briefumschlag ALLES IM BLICK BESONDERS ÜBERSICHTLICHE MONATSPLANER DRUCK4C SPARPORTO VERSION SPARPORTO VERSIONDRUCK4C SPARPORTO VERSIONDRUCK4C 249KALENDER | 1 „MEGA4-MONATS-PLANER4APOSTVERSION“ Kalenderdruck in hellgrau/schwarz, Feiertage in rot, 3-sprachig D/E/F. Mit Datumsschieber.Fertig montiert. Perforierte Kalenderblätter und genutete Rückwand zum portogünstigen Postversand im Maße:B4-Großbrief-Format. ca. 30 x 60 cm O Offsetdruck. Fläche: 300 x 150 mm Preis/Stk.: ab 60 Stück -,55 Werkzeugkosten: Siehe Serviceseiten. D Digitaldruck 4c. Fläche: 300 x 150 mm Preis/Stk.: ab 60 Stück -,99 Einmalige Werkzeugkosten 55,184 314 ohne Druck ab 1,79 184 322 für Druck ab 1,79 2 4-MONATS-PLANER „KONZEPT POST“ Übersichtlicher 4-Monats-Planer mit Extra-Spalte für tägliche Einträge. Kalenderdruck in hellgrau/ schwarz, Feier- und Sonntage in rot. Perforierte Kalenderblätter und genutete Rückwand zum portogünstigen Postversand im B4-Großbrief-Format. Inkl. praktischem Datumsschieber fertig montiert. Maße: ca. 30 x 60 cm O Offsetdruck. Fläche: 285 x 100 mm Preis/Stk.: ab 80 Stück -,55 Werkzeugkosten: Siehe Serviceseiten. D Digitaldruck 4c. Fläche: 285 x 100 mm Preis/Stk.: ab 80 Stück 1,30 Einmalige Werkzeugkosten 55,172 062 ohne Druck ab 1,29 172 054 für Druck ab 1,29 2 „KONZEPT4-MONATS-PLANERPOST“ ab1 29 1 PLANER4-MONATSab 1 79 STÜCKAB STÜCK-PREIS 1.DRUCKFARBE DIGITAL4C 1 1,79 80 1,59 -,55 1,30 250 1,49 -,50 1,10 500 1,39 -,40 -,90 1.000 1,29 -,30 -,70 Druckkosten weitere Farben: siehe Onlineshop STÜCKAB STÜCK-PREIS 1.DRUCKFARBE DIGITAL4C 1 2,25 60 1,95 -,55 -,99 150 1,90 -,50 -,95 500 1,85 -,45 -,85 1.000 1,79 -,35 -,75 Druckkosten weitere Farben: siehe Onlineshop 3 „PRIMUS3-MONATS-WANDKALENDERPOST“
285 x 100 mm Preis/Stk.: ab 150 Stück -,45 Werkzeugkosten: Siehe Serviceseiten. D Digitaldruck 4c. Fläche: 285 x 100 mm Preis/Stk.: ab 150 Stück -,90 Einmalige Werkzeugkosten 55,093 991 ohne Druck ab -,69 094 009 für Druck ab -,69 STÜCKAB STÜCK-PREIS 1.DRUCKFARBE DIGITAL4C 1 1,29 150 1,09 -,45 -,90 250 -,99 -,40 -,85 500 -,95 -,35 -,75 1.000 -,85 -,30 -,65 2.500 -,75 -,28 -,55 5.000 -,69 -,25 -,45 Druckkosten weitere Farben: siehe Onlineshop 3 3-MONATS-WANDKALENDER „PRIMUS POST“ ab 0 69 * Komplettpreis inklusiv einfarbigem, einseitigen Werbeaufdruck in Standardschrift











KALENDERDRUCK MIT IHREM LOGO WERBEN NACH IHREN INDIVIDUELLEN WÜNSCHEN Lieferung nur für den gewerblichen Bedarf. Alle Preise zzgl. MwSt.250 | KALENDER 3 WANDKALENDER BLAU/WEISS inkl. 4c-Druck Blau/weißes Kalendarium, einzeln abreißbare Monatsblätter, praktisch zusammenfaltbar. Die Besonderheit dieses Kalenders: die komplette Rückwand ist bedruckbar. Roter Druck der Sonn- und Feiertage. Rotes Datumsichtfenster für optimalen Überblick. Maße: 33 x 70 cm / 33 x 86 cm D Digitaldruck 4c. Fläche: 330 x 700 mm / 330 x 860 mm Preis/Stk.: ab 50 Stück ., siehe Tabelle Einmalige Werkzeugkosten 55,163 090 3-Monate ab 2,25 163 936 4-Monate ab 2,45 STÜCKAB INKL.3-MONATE4CDRUCK INKL.4-MONATE4CDRUCK 50 4,95 5,45 200 3,95 4,35 500 3,25 3,45 1.000 2,75 2,95 2.000 2,25 2,45 3 WANDKALENDER INKL. 4C-DRUCK ab 2 25 1 „SPECTRUM“3-MONATS-STREIFEN-KALENDER 3-Monats-Planer als Streifenkalender – damit alle Termine immer übersichtlich und auf einen Blick erkennbar sind. Kalenderdruck in hellgrau/schwarz, Feiertage in rot. Dazu ein praktischer Datumsschieber fertig montiert. Maße: ca. 30 x 60 cm O Offsetdruck. Fläche: 280 x 100 mm Preis/Stk.: ab 80 Stück -,65 Werkzeugkosten: Siehe Serviceseiten. D Digitaldruck 4c. Fläche: 285 x 100 mm Preis/Stk.: ab 80 Stück 1,25 Einmalige Werkzeugkosten 55,010 876 ohne Druck ab 1,39 010 841 für Druck ab 1,39 STÜCKAB STÜCK-PREIS 1.DRUCKFARBE DIGITAL4C 1 1,89 80 1,79 -,65 1,25 200 1,69 -,55 1,05 500 1,59 -,45 -,95 1.000 1,49 -,40 -,75 2.500 1,39 -,35 -,65 Druckkosten weitere Farben: siehe Onlineshop 1 STREIFEN-3-MONATS KALENDER ab 1 39 2 3-MONATS-WANDKALENDER Praktischer 3-Monats-Wandkalender mit einzelnen Kalenderblocks. Jeder Block ist einzeln perforiert, praktisch zu falten und preiswert zu versenden. Kalendarium 4-sprachig. Maße: 33 x 70 cm, je Kalendarium 30 x 14 cm O Offsetdruck. Fläche: 300 x 140 mm Preis/Stk.: ab 100 Stück siehe Tabelle Werkzeugkosten: Siehe Serviceseiten. 091 776 ohne Druck 2,95 091 768 inkl. Druck ab 2,19 2 3-MONATSWANDKALENDER ab 2 19 STK.AB 1-FARB.DRUCKINKL. 2-FARB.DRUCKINKL. 3-FARB.DRUCKINKL. 4-FARB-DRUCKINKL. 1002,95 3,15 3,45 3,75 200 2,75 3,053,303,60 300 2,65 2,953,203,50 500 2,45 2,753,103,40 1.000 2,19 2,492,793,19 SPARPORTODRUCK4C VERSION DRUCK4C SPARPORTO VERSION









































































A5 400 SEITEN * Komplettpreis inklusiv einfarbigem, einseitigen Werbeaufdruck in Standardschrift 251KALENDER | 1 CHEFKALENDER 2023 DIN A5, 400 Seiten 400 Seiten Inhalt, jeder Tag eine ganze Seite (Sa./So. zusammen), Jahresplaner, Feiertage, Schulferien, Wochenübersichten, Messetermine Deutschland und Europa, Adressregister. Farbiger, gepolsterter Kunststoffeinband A5, 2 Leselitzen, Eckenperforation. Blindprägung der Jahreszahl 2023 auf dem Rücken. W Werbedruck. Fläche: 110 x 180 mm P Fläche:Folienprägung. 110 x 180 mm Preis/Stk.: ab 40 Stück -,70 Werkzeugkosten: Siehe Serviceseiten. 033 298 schwarz ab 1,89 033 247 blau ab 1,89 184 187 burgund ab 1,89 184 195 grün ab 1,89 Auf Wunsch liefern wir den Chefkalender auch im Einzelversandkarton. 033 302 Einzelversandkarton -,50 STÜCKAB STÜCK-PREIS DRUCK 1. PRÄGUNGFARBE/ 402,7912,99 -,70 150 2,49 -,65 500 2,29 -,55 1.000 1,99 -,45 2.000 1,89 -,35 Druckkosten weitere Farben: siehe Onlineshop 50 040197CHEFKALENDER530schwarz821blau 195.-WERBETIPP* FolienprägungGroßflächigemöglich! 1 CHEFKALENDER 400 SEITEN ab1 89 CHEFKALENDER 2023 KLARE ÜBERSICHT GARANTIERT ERFOLG




























































A5 320 SEITEN DRUCK4CFolienprägungGroßflächigemöglich! 50 CHEFKALENDER218458schwarz040830blau 189.-WERBETIPP* 1 WOCHENTIMER 2023, 26,5 x 22 cm, 144 Seiten Ein Zeitplaner, der auch gefragten Geschäftsleuten geordnete und übersichtliche Termin-Eintragungen ermöglicht. 144 Seiten Umfang, strapazierfähige Fadenheftung. 2 Leselitzen und geschmackvoller, schwarzer Kunstledereinband. Blindprägung der Jahreszahl auf dem Buchrücken. Jeweils auf einer Doppelseite: Wochen- und Tagesaufteilungen, 4-Monatsübersicht und Zeiteinteilung. Dazu: Jahresvorplanung, Messen und Ausstellungen, Schulferien, internationale Feiertage. Entfernungstabelle, internationale Telefonvorwahl. Buchstabiertabelle und Anschriftenverzeichnis. Handelswörterbuch, Klimatabellen, Postentgelte. Maße: 26,5 x 22 x 2 cm W Werbedruck. Fläche: 70 x 50 mm Preis/Stk.: ab 20 Stück 1,50 D Digitaldruck. Fläche: 150 x 80 mm Preis/Stk.: ab 20 Stück 2,95 Datenhandling: einmalig 29,033 468 ab 4,95 STÜCKAB STÜCK-PREIS 1.DRUCKFARBE DIGITAL4C 2016,956,75 1,502,95 50 6,45 1,252,50 100 6,20 -,951,95 250 5,95 -,751,50 500 4,95 -,50-,95 Druckkosten weitere Farben: siehe Onlineshop 1 WOCHENTIMER ab 4 95 26,5 x cm22,2 144 SEITEN DRUCK4C Lieferung nur für den gewerblichen Bedarf. Alle Preise zzgl. MwSt.252 | KALENDER STÜCKAB STÜCK-PREIS DRUCKPRÄGUNG1.FARBE/ DRUCKDIGITAL-4C 5012,792,69 -,65 1,50 100 2,49 -,55 1,25 500 2,29 -,45 1,1.000 2,09 -,40 -,90 2.000 1,89 -,35 -,80 4.000 1,69 -,30 -,70 Druckkosten weitere Farben: siehe Onlineshop 2 CHEFKALENDER 320 SEITEN ab 1 69 2 CHEFKALENDER 2023 DIN A5, 320 Seiten 320 Seiten Inhalt: Jeder Tag auf einer ganzen Seite (Samstag und Sonntag zusammen). Jahresplanung, Feiertage, Schulferien. Gepolsterter Kunststoffeinband im A5 Format, Leselitze, Eckenperforation. Blindprägung der Jahreszahl 2023 auf dem Buchrücken. W Werbedruck. Fläche: 70 x 50 mm, Preis/Stk.: ab 50 Stück -,65 Werkzeugkosten: Siehe Serviceseiten. D Digitaldruck 4c. Fläche: 135 x 205 mm Preis/Stk.: ab 50 Stück: 1,50 Datenhandling: einmalig 29,033 175 schwarz ab 1,69 033 263 blau ab 1,69 163 104 weiß ab 1,69 Auf Wunsch liefern wir den Buchkalender auch im Einzelversandkarton. 033 302 Einzelversandkarton -,60































































* Komplettpreis inklusiv einfarbigem, einseitigen Werbeaufdruck in Standardschrift 253KALENDER | A5 400 SEITEN 1 CHEFKALENDER ab 5 45 1 CHEFKALENDER DIN A5, 400 Seiten Tag für Tag erfolgreich planen. Inhalt: Zweifarbiger Druck, jeder Tag auf einer Seite, vor jedem Monat eine Monatsübersicht. Mit Übersichtskalender 2023/2024, 6-seitigem Vormerkkalender für 2024, auswechselbarem Adressund Telefonverzeichnis, Infoteil für Schulferien, Feiertage, Jahresplanung, Lieferwochen 2023 und 2024, Messen und Ausstellungen in Deutschland und Europa. Mit 2 Leselitzen und Eckenperforation, Jahreszahl auf dem Buchrücken. Gepolsterter Einband, A5-Format. W Werbedruck. Fläche: 110 x 180 mm P Fläche:Folienprägung. 110 x 180 mm Preis/Stk.: ab 15 Stück 1,70 Werkzeugkosten: Siehe Serviceseiten. 033 386 schwarz ab 5,45 033 409 dunkelblau ab 5,45 Auf Wunsch liefern wir den Chefkalender auch im Einzelversandkarton. 033 302 Einzelversandkarton -,50 STÜCKAB STÜCK-PREIS DRUCK 1. PRÄGUNGFARBE/ 1518,958,35 1,70 50 7,95 -,95 100 7,65 -,70 200 7,25 -,65 500 6,95 -,50 1.000 5,95 -,45 2.000 5,45 -,40 Druckkosten weitere Farben: siehe Onlineshop Folienprägunggroßflächigemöglich! A5 440 SEITEN 2 CHEFKALENDER MIT REGISTERSCHNITT, DIN A5, 440 Seiten Für einen schnellen Zugriff auf jeden Monat. Inhalt: Zweifarbiger Druck, 1 Tag pro Seite, vor jedem Monat eine Monatsübersicht. Mit Übersichtskalender 2023 und 2024, 6-seitigem Vormerkkalender für 2024, auswechselbarem Adress- und Telefonverzeichnis, Infoteil für Schulferien, Feiertage, Jahresplanung, Lieferwochen 2023/2024, Messen und Ausstellungen in Deutschland und Europa. Mit 2 Leselitzen und Eckenperforation, Jahreszahl auf dem Buchrücken, goldfarben. 440 Seiten, A5-Format. W Werbedruck. Fläche: 110 x 180 mm P Fläche:Folienprägung. 110 x 180 mm Preis/Stk.: ab 20 Stück 1,70 Werkzeugkosten: Siehe Serviceseiten. 033 450 blau ab 4,95 033 441 schwarz ab 4,95 Auf Wunsch liefern wir den Chefkalender auch im Einzelversandkarton. 033 Einzelversandkarton302 -,50 2 CHEFKALENDER MIT REGISTERSCHNITT ab 4 95 STÜCKAB STÜCK-PREIS DRUCK 1. PRÄGUNGFARBE/ 2017,657,35 1,70 50 6,95 1,40 100 6,75 1,10 250 6,35 -,85 500 5,95 -,60 1.000 5,45 -,40 2.000 4,95 -,30 Druckkosten weitere Farben: siehe Onlineshop 30 041041CHEFKALENDER693schwarz685blau 295.-WERBETIPP*






































































BUSINESS AS USUAL SICHTBAR WERBEN A5 160 SEITEN Lieferung nur für den gewerblichen Bedarf. Alle Preise zzgl. MwSt.254 | KALENDER 3 NOTEBOOK 200 SEITEN ab 3 55 2 LOGBUCH 200 SEITEN ab 3 95 2 LOGBUCH 2023, 200 SEITEN Das hochwertige Buch für‘s Business: Inhalt 200 Seiten, davon 128 Seiten Kalendarium sowie 64 Notizseiten mit Mikroperforation. Das Kalendarium beinhaltet 22 Seiten Informationsteil mit Jahreskalendarien 2023-2024, Intern. Feiertage, Ferientermine, Urlaubsplaner, Jahresübersichtskalender 2023/2024, EntfernungstabelleMessetermine,uvm.Zusätzlich hat das Logbuch 8 Seiten graue Memozettel (zum Abreißen perforiert) sowie eine zusätzliche Einstecktasche am Buchende. Zeichenband. Der Kalender hat eine feste Buchdecke und wird mit silberfarbenem Einband geliefert. Standardmäßig ist das Wort LOGBUCH 23 aufgeprägt. P Prägung in Silber. Fläche: 70 x 30 mm Preis/Stk.: ab 20 Stück -,90 Werkzeugkosten: Siehe Serviceseiten. 286 926 DIN A4 ab 5,95 093 581 DIN A5 ab 3,95 3 NOTEBOOK, 200 SEITEN 200 Notizseiten in modernem Winkelkaro mit Mikroperforation. Zusätzlich 8 Seiten graue Memozettel (längs- und querperforiert zum Heraustrennen) sowie eine Einstecktasche am Buchende. Zeichenband. Das Notebook hat eine feste Buchdecke mit silberfarbenem Einband. Standardmäßig ist das Wort NOTE:BOOK aufgeprägt. P Prägung in Silber. Fläche: 70 x 30 mm Preis/Stk.: ab 20 Stück -,90 Werkzeugkosten: Siehe Serviceseiten. 286 918 DIN A4 ab 4,95 093 590 DIN A5 ab 3,55 STÜCKAB LOGBUCHA4 LOGBUCHA5 BOOKNOTE-A4 BOOKNOTE-A5 PRÄGUNG 2018,956,456,854,858,455,956,554,65 -,90 50 8,25 5,75 6,25 4,45 -,80 150 7,95 5,45 5,95 4,10 -,70 250 7,25 4,95 5,75 3,95 -,60 500 6,95 4,45 5,35 3,80 -,50 1.000 5,953,954,95 3,55 -,40 Druckkosten weitere Farben: siehe Onlineshop 1 BUCHKALENDER 2023, DIN A5, 160 Seiten 160 Seiten, Leselitze, schwarzer gepolsterter Kunststoffeinband, A5 Format. Inhalt: ganze Woche auf einer Doppelseite, Adress- und Telefonregister. 6 seitiger Vormerkkalender für 2024. Umfangreiche Informationsseiten z.B. Messetermine Deutschland und Europa, Jahres- und Wochenübersichten, Ferientermine. W Werbedruck. Fläche: 110 x 180 mm P Folienprägung. Fläche: 110 x 180 mm Preis/Stk.: ab 60 Stück -,60 Werkzeugkosten: Siehe Serviceseiten. 033 167 ab 1,59 1 BUCHKALENDER ab 1 59 STÜCKAB STÜCK-PREIS DRUCK 1. PRÄGUNGFARBE/ 6012,452,20 -,60 150 1,95 -,55 500 1,75 -,50 1.500 1,59 -,35 Druckkosten weitere Farben: siehe Onlineshop 80 197BUCHKALENDER394 245.-WERBETIPP* inNotizbuchA5oder A4 inLogbuchA5oder A4

































































































Mit Stiftschlaufe Mit Jahreszahl 255KALENDER | 2 18-MONATSUNDWOCHENKALENDERNOTIZBUCH „TIMES BIG 18“ ab 3 95 STÜCKAB STÜCK-PREIS 1.DRUCKFARBE 2515,254,95 1,20 100 4,65 -,75 200 4,45 -,60 500 4,25 -,50 1.000 3,95 -,40 Druckkosten weitere Farben: siehe Onlineshop 2
Der diskrete Begleiter. Inhalt: Kalendarium 2023 mit 144 Seiten. Je Woche eine Seite, rechts eine Seite für Notizen. Edles cremefarbenes Papier, Leseband, Gummiband, Falttasche, Einband in kratzfester Lederoptik. Maße: ca. 9 x14 cm W Werbedruck. Fläche: 50 x 35 mm Preis/Stk.: ab 25 Stück 1,20 Werkzeugkosten: Siehe Serviceseiten. 112 387 ab 3,95 3 12-MONATSUNDWOCHENKALENDERNOTIZBUCH „TIMES SMALL 12“ ab 3 95 1 HANDWERKER-KALENDER Große Werbefläche bietet dieser Kalender mit schwarzem, kartoniertem Kunststoffeinband. Für Ihre tägliche Präsenz sorgt der praktische Aufbau des schwarz-rot gedruckten
Inneren: Großzügiges Kalendarium, jahresungebunden und zwölfsprachig. Pro Tag eine Seite, kariert mit Zeiteinteilung von 8-19 Uhr. Eckenperforation. Adressteil. 384 Seiten. Maße: 15,5 x 11,5 x 2 cm W Werbedruck. Fläche: 70 x 40 mm Preis/Stk.: ab 50 Stück -,65 Werkzeugkosten: Siehe Serviceseiten. 033 492 ab 1,99 STÜCKAB STÜCK-PREIS 1.DRUCKFARBE 5012,652,49 -,65 150 2,39 -,60 500 2,29 -,50 1.000 2,09 -,45 2.000 1,99 -,40 Druckkosten weitere Farben: siehe Onlineshop 50 040HANDWERKERKALENDER952 179.-WERBETIPP* 1 HANDWERKERKALENDER ab1 99 STÜCKAB STÜCK-PREIS 1.DRUCKFARBE 2515,254,95 1,20 100 4,65 -,75 200 4,45 -,60 500 4,25 -,50 1.000 3,95 -,40 Druckkosten weitere Farben: siehe Onlineshop * Komplettpreis inklusiv einfarbigem, einseitigen Werbeaufdruck in Standardschrift
3
„TIMESDER12-MONATS-WOCHENKALEN-UNDNOTIZBUCHSMALL12“
Der trendige Begleiter. Inhalt: Kalendarium Oktober 2022 bis März 2024. 208 Seiten. Je Woche eine Seite, rechts eine Seite für Notizen. Edles cremefarbenes Papier, Leseband, Gummiband, Falttasche. Maße: ca. 13 x 21 cm W Werbedruck. Fläche: 60 x 40 mm Preis/Stk.: ab 25 Stück 1,20 Werkzeugkosten: Siehe Serviceseiten. 112 379 ab 3,95
„TIMESDER18-MONATS-WOCHENKALEN-UNDNOTIZBUCHBIG18“




















































































A4 400 SEITEN A5 128 SEITEN 3 WOCHENTIMER „PRESTIGE“ ab 1 99 SEITEN 1 CLUBLINE WOCHENTIMER DIN A5, 144 Seiten Hochwertiger dunkelblauer Kunstleder-Einband mit Blindprägung der Jahreszahl. Mit Übersichtskalender der nächsten Jahre und Feiertage. Übersichtlich und klar strukturiert. 2-farbiges Kalendarium, umfangreicher Informationsteil mit 4 Seiten Urlaubsplaner, Messen und Ausstellungen, Telefonvorwahlen, Adressverzeichnis und aufMonats-Registerstanzung,Reiseinformationen.jedeWocheeinerDoppelseite.Leselitze.144 Seiten. Maße: 24,6 x 17,6 x 1,5 cm W Werbedruck. Fläche: 70 x 50 mm Preis/Stk.: ab 12 Stück 2,45 Werkzeugkosten: Siehe Serviceseiten. 091 311 ab 7,95 WOCHENTIMER ab 7 95 STÜCKAB STÜCK-PREIS 1.DRUCKFARBE 1 11,45 12 10,50 2,45 50 9,95 1,70 150 9,45 1,20 300 8,45 -,95 500 7,95 -,65 Druckkosten weitere Farben: siehe Onlineshop cmWOCHENTIMERCLUBLINE Lieferung nur für den gewerblichen Bedarf. Alle Preise zzgl. MwSt.256 | KALENDER 2 A4-XXL-TIMER 400 Seiten Tag für Tag im Viertelstunden-Takt. Inhalt: jeder Wochentag auf einer Seite, 14 planbare Stunden in viertelstündlicher Einteilung. Jahresübersicht auf jeder Doppelseite. Übersichtskalender 2022 bis 2024, 14 Seiten Projektplanung, 6 Seiten Vormerkkalender für 2024, Adress- und Telefonverzeichnis, Infoteil für Schulferien, Feiertage & Portogebühren. Mit Leseband und Eckenperforation, Jahreszahl auf dem Buchrücken. Schwarzer gepolsterter Einband. Maße: A4-Format W Werbedruck. Fläche: 180 x 280 mm P Folienprägung. Fläche: 180 x 280 mm Preis/Stk.: ab 8 Stück 3,50 Werkzeugkosten: Siehe Serviceseiten. 112 418 ab 13,95 2 A4 XXL-TIMER ab 13 95 STÜCKAB STÜCK-PREIS DRUCK 1. PRÄGUNGFARBE/ 8117,9516,95 3,50 15 16,45 2,75 50 15,95 1,95 100 14,95 1,45 250 13,95 -,95 Druckkosten weitere Farben: siehe Onlineshop 3 WOCHENTIMER „PRESTIGE“ DIN A5, 128 Seiten 128 Seiten Inhalt, jede Woche eine Doppelseite (Sa./So. zusammen), 3-sprachiges Kalendarium (Deutsch, Englisch, Französisch), je Woche 2 Seiten, Hardcovereinband, Eckenperforation, Lesezeichen... W Werbedruck. Fläche: 100 x 50 mm P Folienprägung. Fläche: 100 x 50 mm Preis/Stk.: ab 40 Stück -,80 Werkzeugkosten: Siehe Serviceseiten. 174 620 schwarz ab 1,99 174 638 blau ab 1,99 STÜCKAB STÜCK-PREIS DRUCK 1. FARBE / PRÄGUNG 4013,493,19 -,80 1002,79 -,70 400 2,49 -,60 1.000 2,19 -,45 2.000 1,99 -,40 Druckkosten weitere Farben: siehe Onlineshop





























































































1 BUCHKALENDER „KLASSIK“, DIN A5 Ein Buchkalender mit starkem Cover! Wochenkalender mit 144 Seiten im praktischen A5-Format. Jahreszahlprägung vorne, Kalendarium deutsch, Infoteil mit Entgelte und Pollenflug sowie Blätter für Kontakte und Notizen. Papier 70g/m² Offset FSC, Fadensiegelung und Leseband Maße: 14, 5 x 20,5 cm W Werbedruck. Fläche: 70 x 30mm Preis/Stk.: ab 25 Stück 1,60 Werkzeugkosten: Siehe Serviceseiten. 192 697 blau ab 3,95 192 701 rot ab 3,95 192 710 anthrazit ab 3,95 192 728 natur ab 3,95 2 TASCHENKALENDER „KLASSIK“, 8,7 X 15,3 cm Natürliche Haptik und Robustheit zeichnen dieser Taschenkalender aus. 128 Seiten. Jahreszahlprägung vorne, Kalendarium deutsch, Infoteil mit Entgelte und Pollenfl ug sowie Blätter für Kontakte
und Notizen. Papier 70g/m² Offset FSC, Fadensiegelung und Leseband Maße: 8,7 x 15,3 cm W Werbedruck. Fläche: 55 x 30 mm Preis/Stk.: ab 30 Stück 1,60 Werkzeugkosten: Siehe Serviceseiten. 192 736 blau ab 2,25 192 744 rot ab 2,25 192 752 anthrazit ab 2,25 192 769 natur ab 2,25 STÜCKAB STÜCK-PREIS 1.DRUCKFARBE 2515,755,25 1,60 100 4,95 1,30 250 4,45 1,500 4,25 -,75 1.000 3,95 -,50 Druckkosten weitere Farben: siehe Onlineshop 1 „KLASSIK“BUCHKALENDER ab 3 95 2 „KLASSIK“TASCHENKALENDER ab 2 25STÜCKAB STÜCK-PREIS 1.DRUCKFARBE 3013,953,45 1,60 100 3,25 1,30 250 2,95 1,500 2,45 -,75 1.000 2,25 -,50 Druckkosten weitere Farben: siehe Onlineshop
257KALENDER |



































































































INFORMATIV INS NEUE JAHR GROSSFLÄCHIG WERBEN 352SEITEN Lieferung nur für den gewerblichen Bedarf. Alle Preise zzgl. MwSt.258 | KALENDER 3 TISCHKALENDER „WALL“ Schreibtisch-Querkalender mit farbigem Einband, Serie “Wall“. Wire-OQualitäts-Bindung, 128 Seiten Inhalt. Pro Woche 1 Seite, Jahresübersicht 2023, 4 Seiten Vorschau 2024, 6 Seiten Adress-/Telefonregister, Messen, Schulferien-Übersicht uvm. Jahreszahlprägung auf der Vorderseite. Maße: zugeklappt 30 x 14 x 1,5 cm W Werbedruck. Fläche: 280 x 20 mm, auf Preis/Stk.:Bodenleisteab20Stück 1,60 Werkzeugkosten: Siehe Serviceseiten. 093 493 hellblau ab 4,75 093 508 rot ab 4,75 093 516 orange ab 4,75 2 TASCHENKALENDER „WALL“ Taschenkalender mit 128 Seiten Inhalt, jede Woche auf 2 Seiten. Perforierte Abreißecken. Übersichtskalendarium 2023 und 2024, Messen- und Ferientermine und vieles mehr. P Prägung in Silber. Fläche: 70 x 30 mm W Werbedruck. Fläche: 70 x 30 mm Preis/Stk.: ab 40 Stück -,80 Werkzeugkosten: Siehe Serviceseiten. 082 976 hellblau ab 2,25 082 984 rot ab 2,25 082 992 orange ab 2,25 2 „WALL“TASCHENKALENDER ab 2 25 1 BUCHKALENDER„WALL“ ab 4 95 3 „WALL“TISCHKALENDER ab 4 75 1 BUCHKALENDER „WALL“ Buchkalender mit 352 Seiten Inhalt, jeder Tag 1 Seite, Samstag/Sonntag zusammen. Perforierte Abreiß-ecken. Übersichtskalendarium 2023 und 2024, Messen- und Ferientermine, Vorwahlnummern, kleines Adressbuch, Projektplanungsübersicht. P Prägung in Silber. Fläche: 80 x 50 mm W Werbedruck. Fläche: 80 x 50 mm Preis/Stk.: ab 25 Stück -,85 Werkzeugkosten: Siehe Serviceseiten. 082 941 hellblau ab 4,95 082 950 rot ab 4,95 082 968 orange ab 4,95 STÜCKAB STÜCK-PREIS 1.DRUCKFARBE 2016,155,75 1,60 75 5,65 1,30 150 5,35 1,10 500 4,75 -,90 Druckkosten weitere Farben: siehe Onlineshop STÜCKAB STÜCK-PREIS DRUCK 1. PRÄGUNGFARBE/ 2516,656,25 -,85 100 5,95 -,75 250 5,45 -,65 500 4,95 -,50 Druckkosten weitere Farben: siehe Onlineshop STÜCKAB STÜCK-PREIS DRUCK 1. PRÄGUNGFARBE/ 4013,653,15 -,80 120 2,95 -,70 250 2,45 -,60 500 2,25 -,50 Druckkosten weitere Farben: siehe Onlineshop



























































































Messen
Siehe Serviceseiten. 125 295 blau ab 2,55 125 300 rot ab 2,55 125 318 anthrazit ab 2,55 1 BUCHKALENDER ab 4 95 2 KALENDERTISCH-QUERab 4 75 3 KALENDERTASCHENab 2 55 STÜCKAB STÜCK-PREIS PRÄGUNG 2016,556,15 1,50 100 5,75 -,95 250 5,55 -,85 500 5,15 -,75 1.000 4,95 -,60 STÜCKAB STÜCK-PREIS PRÄGUNG 2016,355,95 1,70 100 5,65 1,30 250 5,45 1,500 4,95 -,80 1.000 4,75 -,70 STÜCKAB STÜCK-PREIS PRÄGUNG 3513,803,60 1,100 3,30 -,90 250 2,95 -,80 1.000 2,55 -,70
BUCHKALENDER Jeder Wochentag auf einer Seite, 14 Stunden in halbstündlicher Aufteilung und viel Raum für Notizen. Adressteil, Jahresprojektplan auf einer Doppelseite, Jahresübersichten 2022 bis 2024, internationalen Feiertagen, Schulferien, Messen, Reiseinformationen & Portogebühren. Mit Leseband und Eckenperforation. Maße: 21 x 14,8 cm P Blindprägung. Fläche: 100 x 50 mm Preis/Stk.: ab 20 Stück 1,50 Werkzeugkosten: Siehe Serviceseiten. 125 238 blau ab 4,95 125 246 rot ab 4,95 125 254 anthrazit ab 4,95
CLASSIC LINE NATURE AUF BESONDERE ART STILSICHER WERBEN CLASSIC LINE „NATURE“. Außen ein hochwertiger Leinen-Einband, innen eine funktionale großzügige Aufteilung. Die Kalender der Classic-Line „Nature“ überzeugen auf ganzer Linie – ob als Buch-, Taschenoder Tischkalender, ob für‘s Business oder den privaten Gebrauch. Dezent und stilvoll zugleich, mit der Jahreszahl in Blindprägung auf dem Einband. 259KALENDER | 1
2 TISCH-QUERKALENDER Schreibtisch-Querkalender mit praktischer Wire-O-Qualitätsbindung. Pro Woche eine Seite, Jahresübersicht 2023 und 2024, Adress- und Telefonregister, Messen und Ferientermine und vieles mehr. Maße: 30,2 x 14,8 cm P Fläche:Blindprägung. 40 x 20 mm Preis/Stk.: ab 20 Stück 1,70 Werkzeugkosten: Siehe Serviceseiten. 125 262 blau ab 4,75 125 279 rot ab 4,75 125 287 anthrazit ab 4,75
Vorwahlnummern uvm. Maße: 15,5 x 9 cm P Fläche:Blindprägung. 65 x 30 mm Preis/Stk.: ab 35 Stück 1,-
3 TASCHENKALENDER Passt in jeder Tasche und lässt dennoch keine Wünsche offen. Jede Woche auf zwei Seiten mit perforierten Ecken, Jahresübersichten 2023 und 2024, Adressteil, internationale Feiertage, und Ferientermine, Portogebühren, internationale Werkzeugkosten:























































































































































































3 LEDER-BUCHKALENDER Ausgabe 2023, 440 Seiten, 2 Leselitzen, zweifarbiger Druck, je Tag eine Seite, jeder Monat mit Monatsübersicht. Mit Übersichtskalender 2023 und 2024, 6-seitigem Vormerkkalender für 2024, auswechselbarem Adress- und Telefonverzeichnis, Infoteil mit Schulferien, Feiertagen, Jahresplanung, Messen und Ausstellungen in Deutschland und Europa, Entfernungstabelle, Postgebühren, Notruf, Abkürzungen, Auslandsvorwahlen. Im Format A5 mit Eckenperforation und gepolstertem karton.Jahreszahlrückenprägung,Ledereinband,GeschenkP Blind- oder Farbprägung. Fläche: 60 x 40 mm Preis/Stk.: ab 8 Werkzeugkosten: Siehe Serviceseiten.
4 LEDER-TASCHENKALENDER Mit 14 Kalendermonaten von November 2022 bis Dezember 2023, Kalenderübersicht und Feiertage, Ferien- und Messetermine. Mit geheftetem Adress- und Telefonverzeichnis, 2 Scheckkartenfächer. Hülle aus echtem Leder mit Moiréefutter. Maße: geschlossen ca. 16,5 x 10 cm P Blind- oder Farbprägung. Fläche: 60 x 40 mm Preis/Stk.: ab 15 Stück 1,90 Werkzeugkosten: Siehe Serviceseiten. 033 343 ab 5,95
Stück 4,50
033 319 ab 16,95 3+4 LEDER-BUCHKALENDER UND LEDER-TASCHENKALENDER Für das Set bieten wir Ihnen einen Preisvorteil von über 10%. Geschenkkarton. P Blind- oder Farbprägung. Fläche: 60 x 40 mm Preis/Set: ab 5 Sets 5,95 Werkzeugkosten: Siehe Serviceseiten. 033 335 für Werbedruck 26,95 127 106 ohne Werbedruck 26,95 4 TASCHENKALENDERLEDERab 5 95 3 MITLEDER-BUCHKALENDERREGISTERSCHNITT ab 16 95 STÜCKAB STÜCK-PREIS 1.DRUCKFARBE 1518,958,45 1,90 50 7,95 1,20 100 6,95 -,95 250 5,95 -,75 Druckkosten weitere Farben: siehe Onlineshop STÜCKAB STÜCK-PREIS 1.DRUCKFARBE 8121,9521,45 4,50 20 20,95 2,50 50 18,95 1,95 200 16,95 -,95 Druckkosten weitere Farben: siehe Onlineshop A5 440 SEITEN nurKALENDERLEDER-TASCHEN-+KALENDERLEDER-BUCH-2695WERBESET* ÖKOLOGISCH UND NACHHALTIG AUS RECYCLINGPAPIER MIT DEM BLAUEN ENGEL 1 NOTE-BOOK RECYCLING A4 Hardcover mit Natura-Einband schwarz matt, unwattiert, 192 Seiten mit Winkelkaro und, Mikroperforation, Einstecktasche, Lesezeichen/Kapitalband, runder Rücken. Maße: 21 x 29,7 cm P Prägung. Fläche: 100 x 50 mm Preis/Stk.: ab 15 Stück 1,95 W Werbedruck. Fläche: 100 x 50 mm Preis/Stk.: ab 15 Stück 1,95 Werkzeugkosten: Siehe Serviceseiten. 192 664 ab 5,95 STÜCKAB STÜCK-PREIS PRÄGUNG 1.DRUCKFARBE Druckkosten50025010050158,451,951,9518,95–7,95-,95-,957,45-,75-,756,95-,65-,655,95-,45-,45weitereFarben:sieheOnlineshop STÜCKAB STÜCK-PREIS PRÄGUNG 1.DRUCKFARBE Druckkosten1.000500250100205,751,501,5016,25–5,25-,75-,754,95-,65-,654,45-,45-,453,95-,35-,35weitereFarben:sieheOnlineshop 2 NOTE-BOOK RECYCLING A5 Maße: 14,8 x 21 cm P Prägung. Fläche: 100 x 50 mm Preis/Stk.: ab 20 Stück 1,50 W Werbedruck. Fläche: 100 x 50 mm Preis/Stk.: ab 20 Stück 1,50 Werkzeugkosten: Siehe Serviceseiten. 192 672 ab 3,95 1-2 RECYCLINGNOTE-BOOK ab 3 95 inNote-BookA5oder A4
260 | KALENDER
Lieferung nur für den gewerblichen Bedarf. Alle Preise zzgl. MwSt.




















































STARKE NATUR 261KALENDER | 1 NOTIZBUCHKALENDER12-MONATS-WOCHEN-UND„TIMESBIG 12 NATURE“ Der natürliche Begleiter. Inhalt: Kalendarium 2023. 208 Seiten. Je Woche eine Seite, rechts eine Seite für Notizen. Edles cremefarbenes Papier, Leseband, Gummiband, Falttasche. Maße: ca. 13 x 21 cm W Werbedruck. Fläche: 60 x 40 mm Preis/Stk.: ab 30 Stück -,95 Werkzeugkosten: Siehe Serviceseiten. 136 202 ab 2,75 2 TISCH„NATURE“QUERKALENDER Schreibtisch-Querkalender mit praktischer Wire-O-Qualitätsbindung. Pro Woche 1 Seite, Jahresübersicht 2023 vorne und 2024 hinten, Adress- und Telefonregister, Messen und Ferientermine uvm. Maße: 30,2 x 14,8 cm W Werbedruck. Fläche: 250 x 20 mm, auf Preis/Stk.:Fußleisteab30Stück -,95 Werkzeugkosten: Siehe Serviceseiten. 136 219 ab 2,95 2 „NATURE“TISCH-QUERKALENDER ab 2 95 1 12UND12-MONATS-WOCHENKALENDERNOTIZBUCH„TIMESBIGNATURE“ ab 2 75 STÜCKAB STÜCK-PREIS 1.DRUCKFARBE 3014,454,15 -,95 100 3,95 -,80 250 3,75 -,75 500 3,45 -,65 1.500 2,95 -,30 Druckkosten weitere Farben: siehe Onlineshop STÜCKAB STÜCK-PREIS 1.DRUCKFARBE 304,4514,65 -,95 150 4,25 -,80 250 3,95 -,75 500 3,75 -,65 1.000 2,95 -,55 2.000 2,75 -,45 Druckkosten weitere Farben: siehe Onlineshop 3 „COMPACT“TISCH-QUERKALENDERRECYCLING Karton-Einband, 112 Seiten, Wire-OBindung weiß. Kalendarium 3sprachig, je Woche 2 Seiten. Maße: 30,4 x 13,5 cm W Werbedruck. Fläche: 298 x 24 mm Preis/Stk.: ab 50 Stück -,90 Werkzeugkosten: Siehe Serviceseiten. 211 127 ohne Druck ab 1,49 192 689 für Druck ab 1,49 STÜCKAB STÜCK-PREIS 1.DRUCKFARBE 502,1512,25 -,90 100 1,95 -,75 250 1,85 -,70 500 1,75 -,50 1.000 1,59 -,40 2.500 1,49 -,30 Druckkosten weitere Farben: siehe Onlineshop 3 „COMPACTTISCH-QUERKALENDERRECYCLING“ ab 1 49



































































































































































Lieferung nur für den gewerblichen Bedarf. Alle Preise zzgl. MwSt.KALENDER
2 QUERKALENDER Hochwertiger dunkelblauer Kunstleder-Einband mit Blindprägung. Mit Übersichtskalender der nächsten Jahre. Feiertage, Schulferien aller Bundesländer. Kalendarium mit Monatseinteilung, Wochenplanung, nach Tag/Uhrzeit unterteilt. Wissenswerte Infos im Anhang. Wire-O-Qualitätsbindung. 128 Seiten. Maße: 30,4 x 14,5 cm W Werbedruck. Fläche: 280 x 17 mm Preis/Stk.:
ab 20 Stück 1,50 Werkzeugkosten: Siehe Serviceseiten. 091 303 ab 5,95 1 QUERKALENDER Aus stabilem schwarzem Kunstleder. 2-farbiges Kalendarium bietet ausreichend Raum für die gesamte Wochenplanung. Wire-O-Qualitätsbindung. Inhalt: 112 Seiten Maße: 30,5 x 13,5 cm W Werbedruck. Fläche: 290 x 20 mm Preis/Stk.: ab 50 Stück -,70 Werkzeugkosten: Siehe Serviceseiten. 211 119 ohne Druck ab 2,25 033 417 für Druck ab 2,25 2 QUERKALENDER ab 5 95 1 QUERKALENDER ab 2 25 3 GROSSER TERMINKALENDERQUERab 1 99 STÜCKAB STÜCK-PREIS 1.DRUCKFARBE 5013,253,05 -,70 150 2,95 -,60 500 2,65 -,50 1.500 2,45 -,35 3.000 2,25 -,25 Druckkosten weitere Farben: siehe Onlineshop STÜCKAB STÜCK-PREIS 1.DRUCKFARBE 2017,957,55 1,50 100 7,35 -,95 500 6,65 -,75 1.000 5,95 -,50 Druckkosten weitere Farben: siehe Onlineshop STÜCKAB STÜCK-PREIS DIGITAL4C 5012,952,60 -,80 150 2,50 -,70 500 2,20 -,50 1.000 1,99 -,40 50 218QUERKALENDER499 209.-WERBETIPP* DRUCK4C 4 QUERKALENDER Hervorragende Querkalender mit Wire-O-Bindung für den Schreibtisch. Stabiler, farbiger Kartoneinband mit verlängerter Unterlage. Kalenderübersicht 2022. Messetermine, Ferientermine, Postentgelte. Format: ca. 30,2 x 14,5 cm W Werbedruck. Fläche: 80 x 20 mm Preis/Stk.: ab 20 Stück 1,50 Werkzeugkosten: Siehe Serviceseiten. 208 310 blau ab 4,55 083 073 rot ab 4,55 STÜCKAB STÜCK-PREIS 1.DRUCKFARBE 2015,805,45 1,50 50 5,35 1,10 100 5,15 -,75 250 4,85 -,55 500 4,55 -,45 Druckkosten weitere Farben: siehe Onlineshop 4 QUERKALENDER ab 4 55
3 GROSSER KALENDERQUER-TERMINVorstehender Unterteil in Einsteckhülle. 2 Seiten/Woche. Deutsche und europäische Feiertage, Schulferien. 112 Seiten. Maße: ca. 32 x 11,5 cm D Digitaldruck. Fläche: 290 x 22 mm, auf Preis/Stk.:Einschubblatt.ab50Stück -,80 Einmalige Werkzeugkosten 29,208 955 ab 1,99
262 |

















































































































































































263KALENDER | 1 QUERKALENDER In silberfarbenem, stabilem Einband. Für gesamte Wochenplanung, nach Tag und Uhrzeit unterteilt. Umfang 128 Seiten. Maße: 30,5 x 13,5 cm W Werbedruck. Fläche: 290 x 20 mm Preis/Stk.: ab 70 Stück -,60 Werkzeugkosten: Siehe Serviceseiten. 211 098 ohne Druck ab 1,69 033 425 für Druck ab 1,69 3 QUERKALENDER Im stabilen, weißen chesWire-O-Qualitätsbindung.Karton-Einband,Übersichtli-Kalendarium.Umfang64Seiten. Maße: 30,5 x 13,5 cm W Werbedruck. Fläche: 290 x 20 mm Preis/Stk.: ab 150 Stück -,50 Werkzeugkosten: Siehe Serviceseiten. 211 022 ohne Druck ab -,69 033 142 für Druck ab -,69 2 QUERKALENDER Stabiler Kunststoff-Einband. 3-sprachiges Kalendarium mit Platz für die gesamte Wochenplanung. Wire-OQualitätsbindung. Umfang 112 Seiten Maße: 31 x 14 cm W Werbedruck.Fläche: 304 x 19 mm Preis/Stk.: ab 80 Stück -,60 Werkzeugkosten: Siehe Serviceseiten. ohne211Druck:055 schwarz ab 1,75 211 063 blau ab 1,75 211 071 weiß ab 1,75 für 019Druck:461 schwarz ab 1,75 047 341 blau ab 1,75 047 681 weiß ab 1,75 1 QUERKALENDER ab 1 69 2 QUERKALENDER ab 1 75 3 QUERKALENDER ab 0 69 STÜCKAB STÜCK-PREIS 1.DRUCKFARBE 1 1,10 150 -,89 -,50 500 -,85 -,45 1.000 -,78 -,35 2.500-,74 -,30 5.000 -,69 -,25 Druckkosten weitere Farben: siehe Onlineshop STÜCKAB STÜCK-PREIS 1.DRUCKFARBE 8012,202,05 -,60 200 1,95 -,55 500 1,85 -,45 1.000 1,75 -,35 Druckkosten weitere Farben: siehe Onlineshop STÜCKAB STÜCK-PREIS 1.DRUCKFARBE 7012,292,19 -,60 150 1,99 -,45 500 1,89 -,35 1.000 1,69 -,25 Druckkosten weitere Farben: siehe Onlineshop 70 042KALENDERQUER-879 219.-WERBETIPP* 80 schwarz197QUERKALENDER302 239.-WERBETIPPWERBETIPP** 150 218QUERKALENDER595 229.* Komplettpreis inklusiv einfarbigem, einseitigen Werbeaufdruck in Standardschrift






















Lieferung nur für den gewerblichen Bedarf. Alle Preise zzgl. MwSt.264 | KALENDER 1 KALENDER–WERBESET 240 Teile Unser Spezialangebot für treue und neue Kunden: 40 Buchkalender 320 Seiten + 200 Leporello-Taschenkalender 7-fach + Adressteil zusammengestellt in einem Set, wahlweise mit oder ohne Werbeaufdruck. Hier ist bestimmt für jeden etwas dabei. Das Set mit Druck beinhaltet den einheitlichen, einfarbigen Werbedruck auf alle Kalender inkl. Klischeekosten für Standardschrift. (Druckfl äche 60 x 30 mm). Logo/Sonderschrift zzgl. 13,ohne Werbedruck: 271 869 schwarz ab 219,271 877 blau ab 219,mit 271Werbedruck:844schwarz ab 269,271 852 blau ab 269,SETS DRUCKOHNE PREIS*SET 1 299,- 369,3 259,- 329,10219,- 269,- 240TEILE299 .2 WERBESET* „KALENDER“ 100 TEILE Mit einem Kalender zeigen Sie größtmögliche Präsenz bei Ihren Kunden. Und das an 365 Tagen im Jahr. Entscheiden Sie je nach Kunde, ob ein Buch- Taschen oder Tischkalender der ideale Werbeträger ist. Bestehend aus 35 Tisch-Querkalendern, 35 Chefkalendern mit Kunstledereinband sowie 30 Taschentimern in schwarz oder weiß Hinweis: inkl. aller Druck- und Vorkosten für Standardschriften, einfarbig. Mehrpreis für Logo/Sonderschriften 13,186 060 schwarz ab 275,193 911 weiß ab 275,SETS PREISSET 1 315,3 295,10 275,100TEILE315 .-














































































































































265KALENDER |
3 TASCHENKALENDER, geheftet Gehefteter Taschenkalender mit Adressverzeichnis und Leselasche. Kalenderübersicht 2023 und 2024. Ferientermine und Messetermine. Übersichtsseite für persönliche Daten. 4 Scheckkartenfächer. Maße: geschlossen 16 x 9,6x 0,3 cm W Werbedruck. Fläche: 60 x 50 mm P Folienprägung. Fläche: 70 x 130 mm Preis/Stk.: ab 150 Stück -,20 Werkzeugkosten: Siehe Serviceseiten. 023 304 blau ab -,69 023 312 schwarz ab -,69 023 329 burgund ab -,69 7-FACHTASCHENKALENDERLEPORELLO
2
ab 0 65 1 14-FACHTASCHENKALENDERLEPORELLO ab 0369KALENDERTASCHENab 0 69 STÜCKAB STÜCK-PREIS DRUCK 1. PRÄGUNGFARBE/ 1501-,95-,89 -,20 500 -,85 -,17 1.000-,79 -,14 2.500 -,75 -,12 5.000 -,69 -,10 Druckkosten weitere Farben: siehe Onlineshop STÜCKAB STÜCK-PREIS DRUCK 1. PRÄGUNGFARBE/ 1501-,95-,89 -,20 500 -,85 -,17 1.000-,79 -,14 2.500 -,75 -,12 5.000 -,69 -,10 Druckkosten weitere Farben: siehe Onlineshop STÜCKAB STÜCK-PREIS DRUCK 1. PRÄGUNGFARBE/ 1501-,90-,85 -,20 500 -,80 -,17 1.000 -,75 -,14 2.500 -,70 -,12 5.000 -,65 -,10 Druckkosten weitere Farben: siehe Onlineshop Folienprägunggroßflächigemöglich 150 04204214-FACHTASCHENKALENDERLEPORELLO723blau758schwarz 189.-WERBETIPP* 150 7-FACHTASCHENKALENDERLEPORELLO042645blau042696schwarz 179.-WERBETIPP* 200 KALENDERTASCHEN 218 482 bunt gemischt 245.-WERBETIPP* * Komplettpreis inklusiv einfarbigem, einseitigen Werbeaufdruck in Standardschrift
TASCHENKALENDER, 14-fach Leporello 16 Kalendermonate von Nov. 2022 bis Feb. 2024. Kalenderübersicht 2023, Feiertage 2023, Ferientermine 2023. Geheftetes Adress- u. Telefonverzeichnis. 4 Scheckkartenfächer. Maße: geschlossen 16 x 9,6 x 0,5 cm W Werbedruck. Fläche: 60 x 50 mm P Folienprägung. Fläche: 70 x 130 mm Preis/Stk.: ab 150 Stück -,20 Werkzeugkosten: Siehe Serviceseiten. 023 353 blau ab -,69 023 361 schwarz ab -,69 023 370 burgund ab -,69
2
TASCHENKALENDER, 7-fach Leporello Ausgabe 2023. Kalendarium, je Monat 1 Seite und 7-fach Leporello Adressenteil, 4 Scheckkartenfächer. Maße: geschlossen 16 x 9,6 x 0,3 cm W Werbedruck. Fläche: 60 x 50 mm P Folienprägung. Fläche: 70 x 130 mm Preis/Stk.: ab 150 Stück -,20 Werkzeugkosten: Siehe Serviceseiten. 023 257 blau ab -,65 023 265 schwarz ab -,65 023 273 burgund ab -,65
1



































komplettgestaltbarindividuell RIESEN NOTIZBLOCK IN 3 VARIANTEN 1 SCHREIBUNTERLAGE Riesen Notizblock, 50 Blatt (70 g/m2) holzfreies Papier auf Papprücken, beidseitig geleimt. Aufteilung: Millimeterpapier oder KaroDesign mit Jahres- oder Zweijahresübersicht. Maße: ca. 40 x 59,5 cm W FlächeWerbedruck.Wochentage: 560 x 90 mm Fläche Millimeter: 405 x 90 mm Fläche Karo-Design: 560 x 80 mm Preis/Stk.: siehe Tabelle Lieferzeit ca. 3-4 Werkzeugkosten:Wochen.SieheServiceseiten. Aufteilung in Millimeter: mm 107 960 ohne Druck ab 3,30 mm 107 986 für Druck ab 3,30 Aufteilung Karo-Design: des 192 605 ohne Druck ab 3,30 des 192 613 für Druck ab 3,30 Individuell: i 171 741 für Druck ab 3,30 1 UNTERLAGESCHREIBab 3 30 STÜCKAB STÜCK-PREIS 1.DRUCKFARBE WEITERE FARBE 1 6,35 108 4,95 1,80 1,20 250 3,75 1,20 1,500 3,65 -,80 -,80 1.000 3,30 -,45 -,60 MILLIMETER INDIVIDUELL KARO-DESIGN 2 WANDPLANER „CLEVER-PLAN“ abwischbar inkl. Marker Dieser abwischbare Wandplaner im Großformat 86 x 59 cm ist hochglanz-spezialbeschichtet für löschbare Beschriftung. Einfach mit dem im Lieferumfang enthaltenen Staedtler-Marker (Schreibfarbe schwarz) beschriften. Bei Korrektur trocken abwischen und neu beschreiben. Fertig! Große Druckfläche. Einzelverpackung. Maße: ca. 86 x 59 cm W Werbedruck. Fläche: 510 x 90 mm Preis/Stk.: ab 50 Stück 5,85 Einmalige Werkzeugkosten.: 55,288 495 ohne Druck 4,65 288 500 für Druck ab 2,39 2 „CLEVERWANDKALENDERPLAN“ ab 2 39 STÜCKAB STÜCK-PREIS DRUCK1C DRUCK4C 50 3,95 5,85 8,15 100 3,65 3,05 4,15 300 3,45 1,30 2,15 500 3,09 1,05 1,70 1.000 2,65 -,75 1,20 2.000 2,39 -,60 1,05 inkl. abwischbarer Marker Lieferung nur für den gewerblichen Bedarf. Alle Preise zzgl. MwSt.266 | KALENDER










































































































































1 POSTERKALENDER Maße: offen 102 x 68 cm W Werbedruck. Fläche: 900 x 80 mm Preis/Stk.: ab 100 Stück siehe Tabelle Werkzeugkosten: Siehe Serviceseiten 035 902 ohne EinzelkartonDruck 4,50 029 254 für Druck ab 1,39 1 POSTER KALENDER ab 1 39 STÜCKAB STÜCKPREIS DRUCK1C DRUCK2C DRUCK3C DRUCK4C 1001,592,85 4,45 6,25 9,95 2001,49 1,60 2,302,955,95 5001,39 -,85 1,201,652,50 2 JUMBO-WANDPLANER 140 x 80 cm Riesenwandplaner mit 2-farbigem Kalendarium schwarz/rot. Insgesamt 15 Monate (inkl. Dezember 2022 und Januar/Februar 2024) im Überblick bietet dieser großformatige WandDieplaner.Version ohne Druck wird geliefert einzeln gerollt in einer Schlauchfolie. Die Druckversion wird geliefert im 25er Pack gerollt. Einzelverpackung auf Wunsch -,50. Maße: 140 x 80 cm O Offsetdruck 4-farbig Fläche: 1300 x 110 mm, Kopfleiste Preis/Stk.: ab 100 Stück siehe Tabelle Werkzeugkosten: Siehe Serviceseiten 093 975 ohne einzelverpacktDruck, 2,95 093 983 inkl. 4C Druck ab 4,15 2 WANDPLANERJUMBOab 2 95 STÜCKAB STÜCKPREISINKL.4C 100 9,55 250 6,25 500 4,15 3 PLAKATKALENDER 67 x 47 cm Jahresübersichtskalender im Großformat. Kalendarium schwarz mit roten Sonn-/Feiertagen. Große Werbefläche. Maße: ca. 67 x 47 cm. Ausführung ohne Druck wird gefalzt im Einzelkarton geliefert, die Ausführung mit Druck ungefalzt. D Digitaldruck 4c. Fläche: Kopfleiste, 550 x 50 mm Preis/Stk.: ab 100 Stück siehe Tabelle Werkzeugkosten: 55,- pauschal 286 942 ohne EinzelkartonDruck, 2,50 286 959 inkl. 4C Druck ab 1,25 STÜCKAB STÜCKPREISINKL.4C 100 4,35 200 3,40 500 1,95 1.000 1,75 2.500 1,45 5.000 1,25 3 PLAKATKALENDER ab 1 25 267KALENDER |











DRUCK4C MADE GERMANYINDRUCK4C2JAHRESKALENDER 40 042MITKALENDERTISCH-ZETTELBOX934 239.-WERBETIPP*500 218KALENDER511weiß, mint und rot sortiert 209.-WERBETIPP* 2 EDELSTAHL TISCHKALENDER 2 Jahre Design-Tischkalender, mit Edelstahl gebürsteter Oberfl äche. Der 3-Monatskalenderblock für 2023 und 2024 mit Kopfl eimung haftet magnetisch auf dem Aufsteller. 3-sprachig (D/E/F), Sonn- und Feiertage rot, Ringmagnet als Datumsschieber. Wird plan geliefert. Danach einfach umknicken und aufstellen. Maße: 10,5 x 23 cm, Aufstellhöhe 18 cm W Werbedruck. Fläche: 80 x 22 mm, oberhalb des Kalendariums. Preis/Stk.: ab 30 Stück -,75 Werkzeugkosten: Siehe Serviceseiten. D Digitaldruck 4c. Fläche: 80 x 25 mm Preis/Stk.: ab 30 Stück 1,60 Datenhandling: einmalig 29,211 080 ohne Druck ab 3,25 112 426 für Druck ab 3,25 2 TISCHKALENDEREDELSTAHL ab 3 25 1 METALL„DESKTOPTISCHKALENDERCOLORS“ 2 Jahre Besonderer Tischkalender aus pulverbeschichtetem Metall. Der 3-Monatskalenderblock für 2023 und 2024 mit Kopfleimung haftet magnetisch auf dem Aufsteller. 3-sprachig (D/E/F), Sonn- und Feiertage rot, Ringmagnet als Datumsschieber. Wird plan geliefert. Danach einfach umknicken und aufstellen. Maße: 10,5 x 23 cm, Aufstellhöhe 18 cm W Werbedruck. Fläche: 80 x 22 mm, oberhalb des Kalendariums. Preis/Stk.: ab 30 Stück -,75 Werkzeugkosten: Siehe Serviceseiten. D Digitaldruck 4c. Fläche: 80 x 25 mm Preis/Stk.: ab 30 Stück 1,60 Datenhandling: einmalig 29,184 200 grün ab 3,25 184 242 blau ab 3,25 184 259 rot ab 3,25 184 267 schwarz ab 3,25 1 „DESKTOPTISCHKALENDERMETALL-COLORS“ ab 3 25 STÜCKAB STÜCK-PREIS 1.DRUCKFARBE DIGITAL4C Druckkosten1.0005002501003014,95––4,65-,751,604,35-,651,404,10-,601,303,85-,55-,993,55-,45-,805.0003,25-,40-,55weitereFarben:sieheOnlineshop 4 MITTISCHKALENDERZETTELBOX Moderne Notizzettelbox (700 Blätter) mit 3-Monatskalender (2 Jahre). Lieferung erfolgt inkl. Schreibgerätehalter. Maße: ca. 10 x 10 x 10 cm. W Werbedruck. Fläche: 90 x 90 mm, auf eine Preis/Stk.:Seite.ab 30 Stück -,60 Werkzeugkosten: Siehe Serviceseiten. D Digitaldruck 4c. Fläche: 100 x 100 mm Preis/Stk.: ab 30 Stück 1,30 Datenhandling: einmalig 29,034 217 ab 3,99 4 MITTISCHKALENDERZETTELBOX ab 3 99 STÜCKAB STÜCK-PREIS 1.DRUCKFARBE DIGITAL4C Druckkosten1.0005002501003015,75––5,35-,601,305,25-,551,104,95-,501,054,45-,45-,953,99-,40-,80weitereFarben:sieheOnlineshop 3 TASCHENKALENDER Karton-Umschlag mit Leinenstruktur. 16 Seiten. Viel Platz für Geschäftstermine und Notizen. Seite 1 für persönliche Daten, danach 2-Jahresübersicht. Mit 13 Kalenderseiten Dezember 2022 bis Dezember 2023. Aufzählung der Ferien- und Feiertage. 2 Seiten Adressregister. Maße: 15,5 x 8,8 cm W Werbedruck. Fläche: 60 x 50 mm Preis/Stk.: ab 500 Stück -,14 Werkzeugkosten: Siehe Serviceseiten. 023 626 weiß ab -,19 023 634 mint ab -,19 023 642 rot ab -,19 184 275 blau ab -,19 184 306 silber ab -,19 STÜCKAB STÜCK-PREIS 1.DRUCKFARBE 1 -,30 500 -,24 -,14 1.000 -,23 -,13 3.000 -,21 -,13 5.000 -,19 -,12 Druckkosten weitere Farben: siehe Onlineshop 3 KALENDERTASCHENab 0 19 STÜCKAB STÜCK-PREIS 1.DRUCKFARBE DIGITAL4C Druckkosten1.0005002501003014,95––4,65-,751,604,35-,651,404,10-,601,303,85-,55-,993,55-,45-,805.0003,25-,40-,55weitereFarben:sieheOnlineshop Lieferung nur für den gewerblichen Bedarf. Alle Preise zzgl. MwSt.268 | KALENDER



































































Druckkosten1.0005003001505012,45–2,25-,551,202,15-,501,-2,10-,45-,901,99-,40-,801,79-,30-,70weitereFarben:sieheOnlineshop
STÜCKAB STÜCK-PREIS 1.DRUCKFARBE DIGITAL4C
Flache Kunststoff-Kassette zum Aufhängen oder durch Umklappen des Fußes zum Aufstellen. 12 zweifarbige Kalenderblätter von Dez. 2022 bis Jan. 2025. Mit Datumsanzeiger. Maße: 16 x 12,5 cmW Werbedruck. Fläche: 100 x 20 mm Preis/Stk.: ab 70 Stück -,55 Werkzeugkosten: Siehe Serviceseiten. D Digitaldruck 4c. Fläche: 100 x 50 mm Preis/Stk.: ab 70 Stück 1,20 Datenhandling: einmalig 29,060 566 grau ab 1,29 060 574 blau ab 1,29 ab
2 3-MONATS WANDKALENDERTISCH-/ ab 1 79 1 3-MONATS-PLANER
1 3-MONATS-PLANER
1 29
WERBETIPP* 60 3197WANDKALENDERMONATS-TISCH-271 189.-WERBETIPP* 50 3043TISCHKALENDERMONATS-033 259.-KALENDERJAHRESWERBETIPP*2DRUCK4C MitüberblickMonatsDRUCK4C 269KALENDER | 2 WANDKALENDER3-MONATS-TISCH-/ Flache Kunststoff-Kassette zum Aufhängen oder durch Umklappen des Fußes zum Aufstellen. 12 zweifarbige Kalenderblätter von Dezember 2022 bis Januar 2025. Maße: ca. 16,2 x 12 x 1,1 cm W Werbedruck. Fläche: 100 x 20 mm Preis/Stk.: ab 50 Stück -,55 Werkzeugkosten: Siehe Serviceseiten. D Digitaldruck 4c. Fläche: 100 x 20 mm Preis/Stk.: ab 60 Stück 1,20 Datenhandling: einmalig 29,033 280 ab 1,79
STÜCKAB STÜCK-PREIS 1.DRUCKFARBE DIGITAL4C Druckkosten1.0005003001507011,95–1,85-,551,201,75-,501,-1,65-,45-,901,55-,40-,801,40-,35-,702.0001,29-,30-,60weitereFarben:sieheOnlineshop 3 3-MONATS-TISCHKALENDER 3-Monatskalender in tollem Design, erstklassig verarbeitet. Einfache Handhabung. Endlos verstellbares Kalendarium. Kein Abreißen oder Auswechseln von Kalenderblättern. Mit Kalender für 2023 und 2024. Geschenkkarton. Maße des Kalenders: 18 x 11 cm. W Werbedruck. Fläche: 90 x 25 mm Preis/Stk.: ab 35 Stück -,95 Werkzeugkosten: Siehe Serviceseiten. 208 795 ab 2,65 3 TISCHKALENDER3-MONATSab 2 65 STÜCKAB STÜCK-PREIS 1.DRUCKFARBE 3514,153,75 -,95 100 3,20 -,55 250 3,05 -,50 500 2,85 -,45 1.000 2,65 -,40 Druckkosten weitere Farben: siehe Onlineshop 4 MOUSE-PAD KALENDER 2023 Praktisches Mouse-Pad mit Jahresübersicht 2023. Damit hat man das ganze Jahr mit Kalenderwochen im Blickfeld. Material: Moosgummi mit 100% Polyester-Textil-Oberfläche. Maße: ca. 190 x 230 x 3 mm W Werbedruck: Auf Wunsch erhalten Sie diesen Artikel auch zusätzlich mit einem Bild oder Ihrem Firmenlogo. Mindestmenge hierfür 24 Stück. Preis auf Anfrage. 094 121 blau ab 3,95 094 130 rot ab 3,95 STÜCKAB STÜCK-PREIS 1 5,25 24 4,95 50 4,65 100 4,35 200 3,95 4 KALENDERMOUSE-PAD2023 ab 3 95 * Komplettpreis inklusiv einfarbigem, einseitigen Werbeaufdruck in Standardschrift





















































125 502
125 535 pink
125 519 weiß
blau
3 KARTONEINBANDTASCHENTIMERab 1 29
2 TASCHENTIMER „LUXUS“ Der Alleskönner im praktischen Taschenformat. Pro Woche eine Doppelseite mit Stundenaufteilung. Jahresplaner 2023 und 2024 auf jeweils vier Seiten sowie Jahresübersichten 2023 und 2024. Projektplaner, Ferientermine, internationale Feiertage, Messen uvm. Stabiler Kunststoffeinband. Maße: 16,5 x 10 cm W Werbedruck. Fläche: 50 x 40 mm Preis/Stk.: ab 50 Stück -,60 Werkzeugkosten: Siehe Serviceseiten. schwarz ab 1,55 ab 1,55 527 ab 1,55 ab 1,55 543
1 WOCHENTIMER „LUXUS“ Pro Woche eine Doppelseite im großzügigen Format, mit Stundenaufteilung und ausreichend Raum für zusätzliche Notizen. Jahresplaner 2023 und 2024 auf jeweils vier Seiten sowie Jahresübersichten 2023 und 2024. Projektplaner, Ferientermine, internationale Feiertage, Messen uvm. Stabiler Kunststoffeinband. Maße: 25 x 16,5 cm W Werbedruck. Fläche: 70 x 40 mm Preis/Stk.: ab 40 Stück -,70 Werkzeugkosten: Siehe Serviceseiten. 125 480 pink ab 2,45 125 471 blau ab 2,45 125 463 weiß ab 2,45 125 498 orange ab 2,45 125 455 schwarz ab 2,45
orange ab 1,55 2 „LUXUS“TASCHENTIMER ab1 55 1 „LUXUS“WOCHENTIMER ab 2 45 STÜCKAB STÜCK-PREIS 1.DRUCKFARBE 4013,453,25 -,70 150 3,05 -,50 500 2,75 -,40 1.000 2,65 -,35 2.000 2,45 -,25 Druckkosten weitere Farben: siehe Onlineshop STÜCKAB STÜCK-PREIS 1.DRUCKFARBE 5012,252,15 -,60 150 1,95 -,50 500 1,85 -,40 1.000 1,65 -,35 2.000 1,55 -,25 Druckkosten weitere Farben: siehe Onlineshop 3 TASCHENTIMER Kartoneinband Komfortabler Taschenkalender mit 128-seitigem Kalendarium. 1 Woche = 2 Seiten, Übersichtskalendarium 2023 + 2024, Schulferien, Feiertage, Zeitzonenübersicht, Telefon-Landesvorwahlen, Projektplaner, Messen, 2 Seiten für Notizen, strapazierfähige Wire-O-Bindung. Kartoneinband. Maße: 9,5 x 16 cm W Werbedruck. Fläche: 50 x 35 mm, vorne Preis/Stk.:untenab 80 Stück -,50 Werkzeugkosten: Siehe Serviceseiten. 102 512 ab 1,29 STÜCKAB STÜCK-PREIS 1.DRUCKFARBE 8011,991,89 -,50 200 1,79 -,45 600 1,69 -,40 1.000 1,59 -,30 2.500 1,39 -,20 5.000 1,29 -,15 Druckkosten weitere Farben: siehe LieferungOnlineshopnurfür den gewerblichen Bedarf. Alle Preise zzgl. MwSt.270 | KALENDER
125
125



















































































































Verschließbarer Deckel sicherfangen 2 RETURNBALL 7 95 STÜCK4
28 cm Hinweis: Für Kinder unter 3 Jahren nicht geeignet. 196 627 69,3 SPIELZEUGEIMER 69.–EIN EIMER ÜBERRASCHUNGENVOLLER 1 BÄREN IM KORB 1 Set / 30 Stück 30 süße Frotteebärchen warten auf
Braun und
Kinder
171 901 37,95 1 BÄREN IM KORB 37 95
zum Knuddeln.
Diese Vollgummibälle im farbenfrohen Fußball-Motiv sind mit einem Gummizug an einer Klettmanschette befestigt, um sicher wieder in der Hand des Werfers zu landen. Maße: je ca. Ø 6 cm Hinweis: Nicht für Kinder unter 3 Jahren geeignet. Lieferung im 4er Set sortiert. SPIELZEUGEIMER, 150 Teile Bunte Mischung Ein ganzer Eimer voller Überraschungen! Mit seinen 150 Bleistiften, Fingerbords, Schlüsselanhängern,Armbändern,Tieren, MiniBasketballkörben & Co. bietet dieser Eimer kleine Aufmerksamkeiten für viele Gelegenheiten, etwa bei Kinderfesten oder auch beim Arztbesuch. Austausch einzelner Teile zugunsten gleich- oder höherwertiger Ware vorbehalten. Maß e: Eimer ca. Ø 23 x jemanden In Beige kuscheln sie sich in einem Körbchen aneinander. Jedes der Bärchen hat sich schick gemacht und trägt für seinen neuen Besitzer eine Schleife. Maße: je ca. 10 cm groß Hinweis: Nicht für unter 3 Jahren geeignet.
225 955 7,95 1 Set / 4 Stück NEU 271SPIELWAREN | 3
























































































GRATISLolliesdazu! GRATIS dazu! Lieferung nur für den gewerblichen Bedarf. Alle Preise zzgl. MwSt.272 | MEHRFÜRSPIELWARENNOCHSPASS 1 SPIELWARENSET 400 Teile + 150 Herzlollies GRATIS • 72 Kreisel • 48 Styropor-Flieger • 50 Bunte Flummis • 72 Wasserspritzpistolen • 36 Leuchtflummis • 72 Mini-Geduldsspiele • 50 Motiv-Kratzbilder Von Langeweile keine Spur. Jeder kleine Kunde findet hier das passende Spiel. Gratis: Als besondere Zugabe enthält dieses Spielwarenset eine Dose mit 150 Stück Herzlollies. Hinweis: Für Kinder unter 3 Jahren nicht geeignet. Austausch einzelner Teile zugunsten gleich- oder höherwertiger Ware vorbehalten 132 603 119,1 SPIELWARENSET 119 .–2 MITSPIELZEUGSORTIMENTPIRATENBOX 408 Teile • 72 Mini-Geduldspielen • 20 City Racer Autos • 48 Styropor-Fliegern • 72 Mini-Pistolen • 72 Kunststoffkreiseln • 24 Seifenblasen-Spiele • 100 Buntstifte Die große garantiertschungskiste!Kindergeburtstagsüberra-BeidiesemSchatzistfürjedenetwasdabei. Gratis: große Piratenbox auf Rollen. Maße: Box 60 x 43 x 50 cm 172 845 119,2 MITSPIELZEUGSORTIMENTPIRATENBOX 119 .–




























































Stabiler GRATISRucksackdazu! 360TEILE GRATISLolliesdazu! 273SPIELWAREN | 3 SPIELZEUGSET 125 Teile, inkl. GRATIS Rucksack • 12 Zauberwürfel • 20 Zaubertafeln • 20 flotte Flitzer • 12 Tiermotiv-Bälle • 60 Flexi-Kugelschreiber Bei diesem 125-teiligen Spielzeugset ist für jeden kleinen Gast etwas dabei! Gratis: stabiler, roter Kinderrucksack. Hinweis: Nicht für Kinder unter 3 Jahren geeignet. Produktaustausch einzelner Teile zugunsten gleichoder höherwertiger Ware vorbehalten. 113 360 49,3 SPIELZEUGSET 49 .–1 GROSSES SPIELZEUG-SET 360 Teile + 150 Lollies gratis • 24 Sets à 12 Straßenmalkreiden • 72 Wasserspritzpistolen • 72 Springbällen • 72 bunte Dinos • 72 Wasserspritztieren • 48 KinderaugenSeifenblasenwerden größer beim Anblick dieser bunten Sammlung kleiner und großer Freizeitspiele. Egal ob für das Firmenfest oder die Praxis. Gratis: Als besondere Zugabe enthält dieses Spielwarenset eine Dose mit 150 Stück Herzlollies. Hinweis: Nicht für Kinder unter 3 Jahren geeignet. 281 325 109,2 SPIELZEUG-SORTIMENT 224 Teile • 10 Stofftier-Schlüsselanhänger • 24 Seifenblasen-Spiele • 25 Tier-Bleistifte • 36 Buntstift-Boxen • 72 Sprungbälle • 50 Mini-Kartenspiele • 6 Return-Bälle Da freuen sich Ihre jüngsten Kunden: Einfach in die Tasche greifen und ein Überraschungsteil herausfischen. Die bunte Sporttasche kann man danach entweder wieder neu füllen lassen oder für die Freizeit nehmen. Gratis: Eine Sporttasche. Hinweis: Nicht für Kinder unter 3 Jahren geeignet. Austausch einzelner Teile zugunsten gleich- oder höherwertiger Ware vorbehalten. 010 583 99,2 SORTIMENTSPIELZEUG99 .–1 GROSSESSPIELZEUG-SET 109 .–

































































SPANNENDES FÜR KLEINE UND GROSSE KUNDEN STÜCK12 Lieferung nur für den gewerblichen Bedarf. Alle Preise zzgl. MwSt.274 | SPIELWAREN 2 SOFT FLYER 1 Set / 12 Stück Diese flexiblen Wurfscheiben in marmorierten Farben sind unzerstörbar und sorgen für dauerhaften Spaß bei Groß und Klein. Material: Naturkautschuk. Maße: Ø ca. 13,5 x 1 cm Hinweis: Nicht für Kinder unter 3 Jahren geeignet. 173 080 19,95 3 BLEISTIFTE „ANIMAL“ 1 Set / 25 Stück Mit diesen Stiften schreibt jedes Kind gerne. Maus, Frosch, Kuh, Katze und Käfer sind liebevoll aus Holz gestaltet und schlenkern lustig ihre Arme und Beine am Stiftende. Inhalt: 25 Bleistifte im Set, 5-fach sortiert, ungespitzt. Maße: 0,7 x 21 cm Hinweis: Nicht für Kinder unter 3 Jahren geeignet. 121 548 13,95 3 „ANIMAL“BLEISTIFTE 13 95 2 SOFTFLYER 19 95 1 WASSER-VOGELSTIMMEN-PFEIFEN Set / 72 Stück sortiert Vogelgezwitscher wie von echten Vögeln. Wenn die Pfeifen mit Wasser gefüllt werden, lassen sich Vogelstimmen beim Hineinpusten perfekt nachahmen. 4-fach farblich sortiert. Hinweis: Nicht für Kinder unter 3 Jahren geeignet. Maße: ca. 7 x 6 x 2 cm 172 239 18,95 1 WASSER STIMMENVOGEL-PFEIFFEN 18 95



















































































BUNT & KREATIV FARBENFROHER MALSPASS schöne Filzstifte mit Wachsmalstiften TEILE5 TEILE4 1 KREISEL 13 95 STÜCK 1 KREISEL 1 Set / 72 Stück 72 bunt gemusterte Kreisel aus neonfarbenem Kunststoff. Maße: ca. Ø 3,5 x 3,5 cm Hinweis: Nicht für Kinder unter 3 Jahren geeignet. Geschenkbox. 023 499 13,95 275SPIELWAREN | 2 STIFTETASCHE „COLOURFUL SCHOOL“ 4 Teile Das ideale Präsent für kreative Kinder: Diese Stiftetasche aus leichtem NonWoven-Vlies kann mit den drei beiliegenden Wachsmalstiften nach Herzenslust bemalt werden. Hinweis: Nicht für Kinder unter 3 Jahren geeignet. Maße: 22 x 13 cm SP Spezialsiebdruck. Fläche: auf Taschenrückseite 140 x 60 mm Preis/Stk.: ab 150 Stück -,35 Werkzeugkosten: Siehe Serviceseiten. 190 077 -,85 3 TURNBEUTEL ZUM BEMALEN „COLOURFUL HOBBY“ 5 Teile Malspaß und Turnbeutel gleichermaßen. Der Turnbeutel aus extraleichtem Non-Woven ist mit einem Motiv bedruckt, das mit den beiliegenden Filzstiften ausgemalt werden kann. Hinweis: Nicht für Kinder unter 3 Jahren geeignet. Maße: ca. 29 x 25,5 x 0,7 cm 186 615 -,99 2 „COLOURFULSTIFTETASCHESCHOOL“ 0 85 3 ZUMTURNBEUTELBEMALEN 0 99




























































2
2 BUNTSTIFT-BOXEN 1 Set / 36 Boxen à 6 Stück 36 Buntstift-Boxen mit jeweils 6 Naturholz-Stiften in verschiedenen Farben. Maße: Einzelkarton ca. 9 x 4,5 cm, Stifte ca. 9 cm lang. Hinweis: Nicht für Kinder unter 3 Jahren geeignet. W Werbedruck. Fläche: auf Vorderseite, 30 x 25 mm. Oder Rückseite, 30 x 45 mm Preis/Set.: ab 12 Sets 9,Werkzeugkosten: Siehe Serviceseiten. 183 406 11,95
50
STÜCK tolle Farben 100STÜCK Lieferung nur für den gewerblichen Bedarf. Alle Preise zzgl. MwSt.276 | SPIELWAREN 3 STRASSEN-MAL-KREIDE, 1 Set / 12 Einzelverpackungen mit je 12 Stück Maße: Kreide je Ø 1 x 8,5 cm Hinweis: Nicht für Kinder unter 3 Jahren geeignet. Im Geschenkkarton. 093 900 9,95
1 Set / 50 Stück Diese „Minis“ passen in jede Tasche. Je 13 Spiele „Schwarzer Peter“ und „Domino“, je 12 Spiele „Memo“ und „Skat“. Mit Spielanleitung. Maße: 4,9 x 3,4 x 1,2 cm Hinweis: Nicht für Kinder unter 3 Jahren geeignet. 022 867 12,95 1 KARTENSPIELEMINI12 95 4 MINI-BUNTSTIFTE 100 Stück Vier Mini-Buntstifte in einer kleinen Papp-Schachtel. Hinweis: Nicht für Kinder unter 3 Jahren geeignet. Maße: Schachtel: 6 x 3,3 x 0,8 cm 186 762 15,95 4 MINI-BUNTSTIFTE 15 95
3 MAL-KREIDESTRASSEN9 95 BUNTSTIFT BOXEN 11 95 1 MINI-KARTENSPIELE







































































































2
2 WASSERSPRITZEN 19
Wasser marsch! STÜCK24 24 STÜCK72 STÜCK72 277SPIELWAREN | 1
030
4 MITSEIFENBLASENSPIEL 15
1
WASSER-SPRITZTIERE 1 Set / 72 Stück Ins Wasser halten und vollsaugenlassen – dann stoßen sie beim Zusammenquetschen einen Wasserstrahl aus. Kunststoff. Lieferung erfolgt bunt gemischt. Maße: je ca. 4,5 x 3 x 2 cm Hinweis: Nicht für Kinder unter 3 Jahren geeignet. Lieferung in Klarsichtdose 297 29,95 WASSERSPRITZEN 1 Set / 72 Stück Ideal für Firmenfeste, den Kindergarten oder Kindergeburtstage oder als willkommene Erfrischung an heißen Sommertagen. Jede Spritze ist einzeln verpackt im Polybeutel. Gehäuse aus durchsichtigem Kunststoff mit farbigem Drücker und Pumpe sowie Verschlussstöpsel. Hinweis: Nicht für Kinder unter 3 Jahren geeignet. Lieferung im Einzelkarton. 272 398 19,95 95 SEIFENBLASEN MIT SPIEL 1 Set / 24 Stück Doppelter Spielspaß durch Kugelfangspiel in jedem Deckel. Einzelkarton. Maße: je Ø 3 x 9,5 cm Hinweis: Nicht für Kinder unter 3 Jahren geeignet. TASCHENLAMPE Set / 24 Stück Ein leuchtend starkes Präsent. Kinder lieben Taschenlampen, insbesondere in diesen knalligen Farben. Im 24er-Set. Maße: Ø 3 x 12 cm Hinweis: Nicht für Kinder unter 3 Jahren geeignet. 932 17,95 95 95
134
171 303 15,95 3 LED
3 TASCHENLAMPELED 17
1 WASSERSPRITZTIERE 29 95 4


















































































ERST DANNBASTELNFLIEGEN Flitzt mitRückzug STÜCK30 Lieferung nur für den gewerblichen Bedarf. Alle Preise zzgl. MwSt.278 | SPIELWAREN 1 SCHMETTERLINGEBUNTE 17 95 4 RENNAUTOS 1 Set / 20 Stück Ideal für die kleinen Kunden beim Zahn- oder Kinderarzt, denn sie verkürzen die Wartezeit erheblich. Aber auch beim Kindergeburtstag ein schönes Mitbringsel. 20 verschiedene Rennautos aus Druckguss und Kunststoff, farbig lackiert. Im Display. Maße 30 x 18 x 2 cm Hinweis: Nicht für Kinder unter 3 Jahren geeignet. 286 186 5,95 3 FLIEGER ZUM ZUSAMMENBASTELN 1 Set / 48 Stück Inhalt: 48 Flieger in je 6 Einzelteile zerlegt, 12 Flugzeugmodelle, Maßstab 1:60. Bedrucktes Styropor, Kunststoff-Propeller. Geschenkkarton. Maße: montiertes Flugzeug 19,5 x 17,5 x 4 cm Hinweis: Nicht für Kinder unter 3 Jahren geeignet. 023 763 19,95 4 RENNAUTOS 5 95 3 FLIEGER-SET 19 95 1 BUNTE SCHMETTERLINGE MIT RÜCKZUG Set / 30 Stk. Diese Schmetterlinge sind nicht nur wunderschön und farbenfroh, sondern entpuppen sich dank Rückzugautomatik auch als fl otte Flitzer. Hinweis: Nicht für Kinder unter 3 Jahren geeignet. Maße: je ca. 6 x 6 x 3 cm 190 583 17,95 2 MITSEGELFLIEGERGUMMI-MOTOR 4 25 2 SEGELFLIEGER MIT GUMMI-MOTOR Großer Spaß für kleine Piloten. Das Segelflugzeug aus bedrucktem natürlichem Balsaholz mit Kunststoffpropeller muss nur zusammengesteckt werden und schon kann es sich, dank des Gummi-Motors, weit in die Lüfte schwingen. Hinweis: Nicht für Kinder unter 3 Jahren geeignet. Maße: Spannweite 35,5 cm 211 313 4,25









































































































































































































































11
1 ZAUBERTAFEL 13 95
3 BLEISTIFTEFLEXIBLE 9 95
Diese Space-Flummys leuchten in der Dunkelheit. Der Gagartikel für Ihre kleinen Kunden. Die Springbälle aus blaufarbigem Gummimaterial haben fluoreszierende Bestandteile, die sich bei Helligkeit aufladen und bei Dunkelheit leuchten. Maße: Ø ca. 33 mm Hinweis: Nicht für Kinder unter 3 Jahren geeignet. 129 546 16,95 4 TIERMOTIV-BÄLLE 95
2 SPRINGBÄLLE 16 95 1
Diese weichen Softbälle eignen sich hervorragend für Spiel und Freizeit. Sie sind sehr robust und strapazierfähig. Bedruckt mit lustigen Tiermotiven erfreuen sie groß und klein. Die Lieferung erfolgt sortiert. Maße: ca. Ø 7 cm Hinweis: Nicht für Kinder unter 3 Jahren geeignet. FLEXIBLE BLEISTIFTE 1 Set / 30 Stück
STÜCK36 leuchtet DunkelnimDunkeln 20 279SPIELWAREN | 4 TIERMOTIV-BÄLLE 1 Set / 12 Stück
101 632 11,95 3
Zum basteln, malen oder spielen: Flexible Bleistifte aus Kunststoff mit Radiergummi in verschiedenen Farben. Maße: Länge ca. 34 cm Hinweis: Nicht für Kinder unter 3 Jahren geeignet. 9,95 MAGISCHE ZAUBERTAFEL 1 Set / 20 Stück
283 232
Ein ideales Geschenk für Kindergeburtstage, Feiern usw.. Die Zaubertafel aus Karton, inkl. Kunststoffzeichenstift. Einfach auf der Kunststofffolie ein Bild malen, wenn es nicht gefällt den Karton rausziehen und es kann wieder von vorne losgehen. Ein unendlicher Spaß für Kinder. Set bestehend aus 20 bunt bedruckten Tafeln. Maße: Tafel ca. 19 x 13 cm Hinweis: Nicht für Kinder unter 3 Jahren geeignet. 094 437 13,95
2 SPRINGBÄLLE MIT LEUCHTEFFEKT 1 Set / 36 Stück





















































Zum Anhängen an Taschen Schlüsselbundoder STÜCK STÜCK24 3 STRAND-REIFEN ZUM AUFBLASEN 2 FARBIG Klein in der Tasche aber Oho am Strand! Diese 2-farbigen Reifen zum schnellen Aufblasen sind ideal zum Spielen und Entspannen. Aus phthalatfreiem PVC . Maße: gefaltet 11,5 x 14 x 1 cm, aufgeblasen Ø 50 x 10 cm Hinweis: Nicht für Kinder unter 3 Jahren geeignet.Keine Schwimmhilfe. SP Spezialdruck. Fläche: 150 x 60 Preis/Stk.:mmab 80 Stück -,70 Werkzeugkosten: Siehe Serviceseiten. 223 576 weiß/blau ab -,99 223 584 weiß/rot ab -,99 223 592 weiß/gelb ab -,99 223 605 weiß/grün ab -,99 223 613 weiß/orange ab -,99 STÜCKAB STÜCK-PREIS 1.DRUCKFARBE 801,5911,79 -,70 1501,49 -,65 5001,40 -,60 7501,35 -,55 1.5001,30 -,50 3.0001,15 -,45 5.000-,99 -,40 Druckkosten weitere Farben: siehe Onlineshop KLEIN ABER OHO MACHT SPASS UND FÖRDERT DIE FANTASIE 1 PLOPP BUBBLES ANHÄNGER Set / 24 Stk. Die weichen Silikonhütchen lassen sich mit leichtem Widerstand eindrücken und erzeugen dabei ein „Plopp“-Geräusch. Sind alle Blasen eingedrückt, kann das Spiel einfach umgedreht und neu begonnen werden. Es wirkt analog einem Stressball und hilft somit Stress abzubauen. Die ideale Beschäftigung für Kinder und Erwachsene. Sortiert. Maße: ca. 8 x 5 cm Hinweis: Nicht für Kinder unter 3 Jahren geeignet. 220 582 19,95 1 PLOPP ANHÄNGERBUBBLES 19 95 2 KLEINE FIGURENDINO-NEON 9 95 2 KLEINE DINO-FIGUREN NEON Set / 36 Stk. T-Rex, Diplodocus & Konsorten sind los! Die bunten Dinos erobern jedes Kinderzimmer und schaffen es sogar bis auf manchen Bürotisch! Vielfach sortiert. Maße: je ca. 5,5 cm Hinweis: Nicht für Kinder unter 3 Jahren geeignet. 220 599 9,95 3 STRAND- REIFEN ZUM AUFBLASEN ab 0 99 Lieferung nur für den gewerblichen Bedarf. Alle Preise zzgl. MwSt.280 | SPIELWAREN


















































































































































































Absolut trendy STÜCK60 STÜCK25 SOVIEL FARBE MUSS SEIN FREUDE AM SCHENKEN 1 STEMPEL SMILE Set / 60 Stk. Die bunten Stempel mit witzigen Smile-Motiven machen jedes Blatt lebendig und lassen sich gut ausmalen. 10 Motive und Kunststoffgehäuse.Stempelfarben.Display. Maße: Stempel Ø ca. 2,5 x 3,5 cm Hinweis: Nicht für Kinder unter 3 Jahren geeignet. 220 574 29,95 1 STEMPEL SMILE 29 95 2 FACESFUNNYFLUMMIS 9 95 2 FLUMMIS FUNNY FACES Set / 25 Stk. Die transparenten Springbälle mit vielen verschiedenen Smiley-Motiven springen in jedes Kinderherz. Toll als Werbegeschenk für die Praxis & Co. Sortiert. Maße: Ø ca. 3 cm Hinweis: Nicht für Kinder unter 3 Jahren geeignet. 220 603 9,95 3 RAINBOW ARMBÄNDER Set / 24 Stk. Diese modischen Neonarmbänder sind absolut trendy und damit bei jungen Menschen als Geschenk überaus beliebt. Farbig sortiert. Maße: Ø ca. 9 cm Hinweis: Nicht für Kinder unter 3 Jahren geeignet. 220 611 9,95 3 ARMBÄNDERRAINBOW 9 95 281SPIELWAREN |



























































































































































































IM4SET STÜCK12 Aufbewahrungsboxfarb.sortiert Lieferung nur für den gewerblichen Bedarf. Alle Preise zzgl. MwSt.282 | SPIELSPIELWAREN& SPASS GIVEAWAYS FÜR ALLE KINDER 1 FUNNY-SPIELZEUG-SET 253 Teile • 1 Dose à 250 Sadex-Traubenzucker mit Vitamin C • 20 Spielzeug-Autos • 30 flexible Bleistifte • 72 Neckbälle mit Schnur • 72 Mini-Geduldspiele • 20 Zaubertafeln • 12 Puzzle-Würfel • 25 Bleistifte Animals Spaß ohne Grenzen, Fantasie an die Macht! Der Nachmittag gehört dem spielerischen Erwachen und hier ist genau was die Kinder brauchen. Gratis: Als besondere Zugabe enthält dieses Spielwarenset eine Funny-Box auf Rollen Maße: 58 x 39 x 31 cm, Füllmenge: ca. 70 l Hinweis: Für Kinder unter 3 Jahren nicht geeignet. 145 947 129,Auch einzeln lieferbar 223 808 farblichAufbewahrungsboxsortiert 19,95 1 FUNNY-SPIELZEUG-SET 129 .–3 SPRINGSEILE 1 Set / 4 Stück Seilspringen macht nicht nur Spaß, sondern ist auch das perfekte Training für Ausdauer, Koordination und Schnelligkeit Maße: 240 cm Hinweis: Für Kinder unter 3 Jahren nicht geeignet. 196 153 9,95 3 SPRINGSEILE 9 95 2 PUZZLEWÜRFEL 1 Set / 12 Stück Der Puzzlewürfel begeistert schon seit mehr als 30 Jahren mit Millionen Kombinationsmöglichkeiten. Es ist das meistverkaufte Puzzle der Welt. Einzelverpackung. Maße: Würfel 5,2 x 5,2 x 5,2 cm Hinweis: Nicht für Kinder unter 3 Jahren geeignet. 090 706 8,95 2 PUZZLEWÜRFEL 8 95
















































































































DANKESET 1 WERBESET „DANKE“ 466 TEILE • 16 Heidel Schokotäfelchen • 50 Fruchtgummis • 200 Bonbons • 100 Heidel Naps • 100 Traubenzucker Es gibt viele Möglichkeiten Danke zu sagen. Besonders charmant sind die unterschiedlichen süßen Naschereien, die wir in diesem Set für Sie zusammengestellt haben. 195 089 46645,-TEILE45 .283SÜSSWAREN |

































































































Mit VitaminwertvollemD&Calcium EINE KLARE BOTSCHAFT DER AUFMERKSAMKEIT Lieferung nur für den gewerblichen Bedarf. Alle Preise zzgl. MwSt.284 | SÜSSWAREN 3 „DANKE“-TRAUBENZUCKER DEXTRO ENERGY 1 Set / 100 Stück / 108 g Traubenzucker bringt verbrauchte Energie zurück. Eine schöne Art „Danke“ zu sagen. Kleine Quadrate einzelverpackt in transparenten Beuteln. 285 505 8,95 3 „DANKE“-TRAUBENZUCKERDEXTRO-ENERGY 8 95 4 SONNENBÄRCHEN FRUCHTGUMMIS mit Vitamin D/ Calcium, 50 x 10 g Set Mit diesen Sonnenbärchen bringen Sie Gesundheit zu Ihren Kunden und Partnern. Die feinen Gummibärchen im fruchtig-frischen Aroma von Zitrone und Orange begeistern nicht nur durch ihren Geschmack, sondern durch den hohen Anteil an Vitamin D und Calcium. Verpackt in 50 x 10 g Tüten mit der Botschaft „Bleib gesund“. Maße: Tüte 9 x 6 cm 214 498 14,95 4 FRUCHTGUMMISSONNENBÄRCHEN 14 95 IM50SET 1 „DANKE“ FRUCHTGUMMI, 1 Set / 50 Stück Eine klare Botschaft der Aufmerksamkeit. Danke! Wie lecker und fruchtig! 10% Fruchtanteil, ohne künstliche Farbstoffe. 50 Tüten mit je 12 g. 135 672 16,95 1 FRUCHTGUMMI„DANKE“ 16 95 2 TÜTEN MIT 15 G GUMMI-BÄRCHEN, 1 Set / 100 Tüten Ca. 19 Gummibärchen je Tüte, alle fruchtig schmackhaft und ohne künstlichen Farbstoff. Tüten mit Aufdruck: „Ein bäriges Dankeschön“. Einzelkarton. Maße: 10 x 7 cm 026 887 24,95 2 TÜTEN GUMMIBÄRCHENMIT 24 95












































































in 4 Farben 150STÜCK 250STÜCK Kilo1 4 FRUCHTGUMMI-HERZEN 1 Set / 100 Tüten / 1.100 g Ohne künstliche Farbstoffe.Lieferung im Einzelkarton. 074 101 21,95 HERZENFRUCHTGUMMI-FRUCHTGUMMIDANK! 21,95 285SÜSSWAREN | 1 HERZLUTSCHER, 1 Set / 150 Stück / 975 g Herzförmige Lutscher sind eine süße Überraschung für ihre Kundschaft. Geschmack Tutti-Frutti, 6,5 g je Lutscher. Maße: Dose Ø 17 x 20 cm 111 423 12,95 1 HERZLUTSCHER 12 95 2 SADEX TRAUBENZUCKER MIT VITAMIN C 250 Stück in Dose 650 g Traubenzucker Bonbons liefern nicht nur wertvolle Energie, sondern schmecken auch einfach köstlich. Die Sadex Traubenzucker Bonbons in den Geschmacksrichtungen Himbeer, Orange und Zitrone sind einzeln verpackt und erhalten neben Traubenzucker auch Vitamin C. Maße: Dose Ø 14 x 14,5 cm Inhalt: 650 g 172 100 9,95 3 „DANKE“ FRUCHTBONBON-MISCHUNG 1000 g Sagen Ihren Kunden auf besonders „süße” Art „Danke”– Fruchtbonbons mit Kirsch-, Orangen-, Zitronen- und Apfelgeschmack. Alle Bonbons hygienisch einzeln verpackt. Lieferung im Polybeutel. Inhalt: 1000 g 220 871 10,95 2 MITZUCKERTRAUBEN-SADEXVITAMIN C 9 95 3 „DANKE“FRUCHTBONBON-MISCHUNG 10 95




















































































































und Rätseln für die Reise GRAMM180 1 „ SWEET SÜSSWARENREISEKOFFERSTORIES“MIX 4 95 Lieferung nur für den gewerblichen Bedarf. Alle Preise zzgl. MwSt.286 | SÜSSWAREN 2 HARIBO DOSE mit 100 Minibeuteln / 980 g Süße Geschenke sorgen immer für Begeisterung. Egal ob bei Kinderfesten, zum Geburtstag, Schulanfang, als Belohnung oder „nur so”. Sie wissen ja, HARIBO macht Kinder froh und Erwachs‘ne ebenso. 022 449 Gummibärchen 10,95 2 HARIBO-DOSE 10 95 100STÜCK 3 FRUCHTGUMMI-AUTOS, 1 Set / 100 Tüten / 1.000 g Kleine Tütchen mit leckeren Fruchtgummis in Autoform. In 3 Farben, ohne künstliche Farbstoffe. Hinweis: Lieferung im Einzelkarton. 067 346 24,95 3 AUTOSFRUCHTGUMMI24 95 100STÜCK 1 SWEET STORIES REISEKOFFER SÜSSWAREN MIX 180 g gemischte Süßwaren Dieser Reisekoffer ist die mega spaßige Süßwarenmischung für kleine Entdecker! Mit lustigen Spielen auf der Rückseite – zum Spielen & Lernen! Der Koffer – vollgepackt mit den bekanntesten Kiosk-Bestsellern – versüßt jede Fahrt in den Urlaub! 3-fach sortiert. Maße: (Verpackung) 19 x 20 x 4,5 cm 221 358 4,95




























































































































































































































IM16SET STÜCK60 3 DANKESCHÖN-BOX 39 95 287SÜSSWAREN | 2 HEIDEL DANKE SCHOKOLADEN TÄFELCHEN Set / 16 Stk. Die leckerste Art, sich bei Kollegen, Kunden oder Freunden zu bedanken! Die 16 Mini-Täfelchen aus feinster Edel-Vollmilchschokolade zergehen auf der Zunge und sind jeweils mit unterschiedlichen Dankesworten bedruckt. Inhalt: 80 g, Einzeltäfelchen 5 g Maße: 14 x 6 x 4 cm 185 577 3,95 1 DANKESCHÖN SCHOKOTALER RUNDDOSE 60 Stk. / 480 g Dieser süße Dank kommt immer gut an: 60 einzeln verpackte Taler (8 g) aus köstlicher Vollmilchschokolade, bedruckt mit einem herzlichen Dankesgruß. Maße: Dose Ø 12,4 x 10 cm 207 235 14,95 3 mitDANKESCHÖN-BOXMarkensüßwaren 1,7 kg In manchen Zeiten ist ein Dankeschön der einfachste und beste Weg direkt ans Herz zu gehen und eine Botschaft der Anerkennung zu überbringen. Ob für Mitarbeiter oder Kunden, mit dieser Snackbox der Superlative wird Ihr Dankeschön garantiert mit Begeisterung entgegengenommen. Füllung kann variieren. Inhalt: 3 x 45g M&M Peanut 5 x 100g Ritter-Sport Tafelschokolade 4 x 50g Twix 3 x 50g Snickers 3 x 51g Mars 3 x 100g Haribo 3 x 20g funny-frisch Brezli 3 x 20g Gofi Sesam 3 x 50g Ültje Erdnüsse pikant 20er Herba Früchtetee 203 620 39,95 2 HEIDEL TÄFELCHENSCHOKOLADENDANKE 3 95 1 RUNDDOSESCHOKOTALERDANKESCHÖN 14 95






























































































100STÜCK DANK!HERZLICHEN STÜCK60 DANK! MADE GERMANYIN60IMSET Lieferung nur für den gewerblichen Bedarf. Alle Preise zzgl. MwSt.288 | SÜSSWAREN 2 DANKE-NAPOLITAINS, 300 g (ca. 100 Stück) Sagen Sie „Danke“ zu Ihren Kunden mit einer kleinen Aufmerksamkeit. 100 Stück Schokotäfelchen à 3 g helfen Ihnen dabei. Im Polybeutel. 084 433 7,95 1 VOLLMILCH-HERZEN, 1 Set / 100 Stück / 900 g Massive Vollmilch-Schokolade, jedes Herz mit Aufschrift „Vielen Dank“. Maße: ca. 4 cm groß Hinweis: Lieferung im Geschenkkarton. 066 835 22,95 2 NAPOLITAINSDANKE7 95 1 HERZEN 22 95 4 SCHOKOTALER EMOTIONEN-SYMBOLE 1 Dose / 60 Stück „Just smile“ – das ist das Motto dieser fröhlichen Emotionen-Schokotaler aus Vollmilchschokolade von „DreiMeister ®“. Und wir versprechen Ihnen, es funktioniert! Inhalt : 480 g 165 284 13,95 4 EMOTIONENSCHOKOTALER 13 95 3 „GUTE RUNDDOSESCHOKOTALERFAHRT“ 17 95 3 „GUTE FAHRT“ SCHOKOTALER RUNDDOSE 60 Vollmilchtaler, 480 g Köstliche Taler aus Vollmilchschokolade. Mit freundlicher Botschaft zum Thema Mobilität und zur Freude aller Verkehrsteilnehmer. Maße: (Verpackung) 10 x Ø 12,5 cm 220 822 17,95





































































































































SMALL & BEAUTIFUL STÜCK 289SÜSSWAREN | 3 REISEKOFFER AUS METALL gefüllt mit 126 g Markensüßwaren Ein weitgereister Koffer bis zum Rand mit süßen Köstlichkeiten gefüllt! Jeder Koffer enthält: • 1x HARIBO Mini-Fruchtgummi Beutel Goldbären • 1x HARIBO Mini-Fruchtgummi Beutel Happy Cola • 1x MANNER-Neapolitaner Waffel • 1x MAOAM-Würfel • 1x SUN RICE crunchy Puffreis mit Cerealien & Nuss • 1x SUN RICE crunchy Puffreis mit Cerealien & Kakaocreme • 4x ROCKS -Bonbons Orange • 2x Original MUH-MUHS Sahne-Toffees Maße: 10,5 x 5,3 x 14 cm 201 589 7,95 2 GOLDTÄFELCHEN 19 95 1 RITTER SPORT MINI BUNTE VIELFALT 1 Set / 84 Stück/ 1.550 g Im Displaykarton mit 7 verschiedenen Sorten: Joghurt, Vollmilch, Marzipan, Haselnuss, Knusper-Keks, Knusper-Flakes und Nougat. 026 918 29,95 1 RITTER SPORT MINI BUNTE VIELFALT 29 95 2 GOLDTÄFELCHEN, 1 Set / 60 Stück 60 Stück Mini-Täfelchen aus Edel-Vollmilch-Schokolade von der Confiserie HEIDEL, je 10g (= 600g). Eingepackt in Goldfolie in Form eines kleinen Goldbarrens. Damit machen Sie kleinen und großen Kunden eine Freude. Hinweis: Lieferung im bruchsicheren Karton. Maße: Täfelchen je 5,7 x 3,7 cm 283 739 19,95 3 REISEKOFFER AUS METALL Gefüllt mit 126 Markensüßwareng 7 95













































NEU Fürunsere liebeKolleginSarah KärtchenBeschriftenzum Lieferung nur für den gewerblichen Bedarf. Alle Preise zzgl. MwSt.290 | WEIHNACHTEN 1 GLÜCK ADVENTSKALENDERMARMELADE34 95 1 GLÜCK ADVENTSKALENDERMARMELADE Verschenken Sie eine Extraportion Glück. Hinter den Türchen dieses Adventskalenders versteckt sich Tag für Tag eine fruchtige oder honigsüße Portion GLÜCK im Mini-Glas. Die 8 verschiedenen Fruchtaufstriche (je 28 g) und die 2 Sorten Sommerhonig (je 32 g) sind einfach köstlich. Maße: 38,1 x 38,1 x 2,6 cm 212 357 34,95 MitFasergussnachhaltigemInlay 2 WUNDERTÜTEWEIHNACHTSFEIER 7 95 2 WUNDERTÜTEWEIHNACHTSFEIER
Unverzichtbar für die Weihnachtsfeier oder als weihnachtlicher Gruß für einen lieben Menschen. Feiern Sie online mit Kollegen oder Mitarbeitern, dann ist mit der Weihnachtsfeier Wundertüte viel Spass garantiert. Eine lustige Anleitung gibt tolle Tipps und Ideen, wie ein bisschen Spass in die Weihnachtsbude kommt. Mit unserem leckeren Höllinger Traubensaft, ohne Zuckerzusätze, zaubert man im Handumdrehen einen leckeren, alkoholfreien Punsch. Inhalt: roter Traubensaft mit stillem Wasser ( Fruchtgehalt mind. 60%) 200 ml, Punschgewürz 5 g, Weihnachtslied zum Singen, Spaß und Rätselkarte für Online Weihnachtsfeier, Punschrezept, Geweih zum Umbinden. Inhalt kann varrieren. Maße: 14 x 22 x 4 cm 224 421 7,95















































































































Maße: 10 x 0,5 cm L Lasergravur. Fläche: 100 x 5 mm Preis/Stk.: ab 50 Stück -,75 Werkzeugkosten: Siehe Serviceseiten. 215 242 ab 1,65 2 WEIHNACHTS-PRÄSENTKORB Über diesen Luxus-Präsentkorb, gefüllt mit vielen Köstlichkeiten, werden sich Ihre Kunden garantiert freuen! Der Picknickkorb enthält: 1 Flasche Original Nürnberger Glühwein, 1 Glühweinglas, 150 g gefüllte Lebkuchenherzen und 200 g Spekulatius. Alles bruchsicher verpackt! Maße: Korb ca. 31 x 23 x 14 cm 113 669 25,95 1 SPROUT WEIHNACHTSBAUMBLEISTIFT ab 1 65 2 PRÄSENTKORBWEIHNACHTS25 95 STÜCKAB STÜCK-PREIS GRAVURLASER1 2,65 50 2,45 -,75 100 2,25 -,65 2502,05 -,55 500 1,95 -,45 1.5001,65 -,35
1 SPROUT BLEISTIFT Weihnachtsbaum Sprout, der patentierte Bleistift der wächst, wenn er nicht mehr zum Schreiben benutzt werden kann. Denn sobald nur noch ein Bleistiftstummel übrig ist, wandert dieser nicht in den Müll, sondern in den Blumentopf. Die wasserlösliche Samenkapsel enthält bestes Samengut für einen neuen Weihnachtsbaum.
1.
2.
NEU 291WEIHNACHTEN |
Anstatt diesen Stift wegzuwerfen, können Sie ihn einpflanzen, um daraus eine Fichte zu züchten. Die Sprout Stifte sind 100% nachhaltig. Sie sind aus zertifiziertem FSC-Lindenholz hergestellt und bestehen aus biologisch abbaubaren und natürlichen Materialien. Nachdem der Bleistift aufgebraucht ist, drücken Sie den Sprout bis zum oberen Rand der Samenkapsel in die Erde. Wasser, Licht und Liebe nicht vergessen! Der Fichte beim Wachsen zusehen!


















































































































NEU
Der Adventskalender hat ein freies Feld zum Beschriften und ist personalisierbar. Er besteht aus starkem Karton zum praktischen Hinstellen. Die Balsamessige und Olivenöle sind in kleinen wiederverschließbaren 20 ml Glasfläschchen (Kropfhalsflaschen) abgefüllt. Inhalt : 480 ml Maße: 27 x 39 x 10 cm 223 710 59,95
2 GOOD HAIR PASTAGESCHENKSETDAY&OLIVENÖL 29 95
NEU
1 ADVENTSKALENDER BALSAMICO & ÖL 24 Überraschungen versprechen ein Fest für den Gaumen! Perfekte Geschenkidee für Küchenfreunde. An jedem Tag im Dezember findet man im Adventskalender verschiedene wundervolle extra native Olivenöle aus Spanien, kostbare Original Aceto Balsamico oder Condimento di Modena I.G.P. oder fantastische Vinaigrettes. Bereiten Sie mit den Ölen und Essigen in vielfältigen Geschmacksrichtungen geniale Salate, Speisen und Soßen zu und erleben unwiderstehliche Geschmackseindrücke.
Holz-Präsentbox bestehend
Team.
Wasser Zutaten Olivenöl:
Kräuter mit Toskana-Aromen Inhalt: 500 g Pasta und 250 ml Olivenöl Maße: 29 x 16,5 x 6,5 cm 224 260 29,95 Freies Feld Beschriftenzum 1 BALSAMICOADVENTSKALENDER&ÖL 59 95 Lieferung nur für den gewerblichen Bedarf. Alle Preise zzgl. MwSt.292 | WEIHNACHTEN
GOOD HAIR GESCHENKSETDAYPASTA & OLIVENÖL
Good Hair Day Pasta & nativem Olivenöl extra im Wood Design. Zutaten Pasta:
extra natives Olivenöl,
2
Ein unschlagbares Ansprechende aus Hartweizengrieß aus kontrolliert biologischem Anbau, Kaltgepresstes natürliche









































GOOD
NEU 293WEIHNACHTEN | GOODPASTAHAIRDAY
2
GOOD HAIR FETTUCCINEDAYALVINO
Original italienische Spaghetti, hergestellt in der Region Umbrien nach traditionellem Bronzeverfahren “al bronzo”. Hierbei wird der frische PastaTeig aus Hartweizengrieß und Ei durch eine Form aus Bronze gepresst. Dies verleiht der Pasta eine raue Oberfläche, die nach dem Kochen die Sauce besser an ihr haften lässt. Zutaten: Hartweizengrieß, getrocknete Tomaten, Spinat, Rote Beete Menge: 500 g Maße: 9,5 x 27 x 2,5 cm 224 243 7,95
4 HAIR DAY SPAGHETTI TRICOLORE
12 x 36 x 2,8 cm 196 936 9,95 4 GOOD HAIR DAY BIO SPAGHETTI TRICOLORE 7 95 3 GOOD HAIR DAY TRECCIA NUDELZÖPFEDORO 9 95 2 GOOD HAIR FETTUCCINEDAYALVINO 7 95 1 GOOD HAIR DAY BUTTERFLY 1960‘S Original italienische Farfallone (Schmetterlingsnudeln), so fröhlich bunt wie ein Technicolor-Film aus den 60er Jahren. Das Verpackungsdesign stammt von der preisgekrönten Gestalterin Nikita Konkin. Zutaten: Hartweizengrieß, getrocknete Tomaten, Spinat, roter Mangold, schwarze Karotten, Kurkuma. Menge: 500 g Maße: 12,5 x 31 x 8cm 214 004 7,95 1 GOOD HAIR DAY BUTTERFLY 1960‘S 7 95 NEU
224 251 7,95 3 GOOD
Diese getrockneten Fettuccine wurden nach traditionellem Bronzeverfahren „al bronzo“ in Italien hergestellt. Diese Nudeln sind mit Wein und roter Beete verfeinert, die durch die außergewöhnliche Verpackung rötlich hervorschimmern. Zutaten: Hartweizengrieß aus kontrolliert biologischem Anbau, Wein (3%), Rote-Beete-Pulver Menge: 250 g Maße: 14 x 18 x 7,5 cm HAIR DAY TRECCIA DORO NUDELZÖPFE So originell haben Sie Ihre Pasta noch nie genossen: original italienische Spaghetti zu zwei kunstvollen Zöpfen geflochten. „al bronzo“ Spaghetti sind bekannt dafür, dass sie Soßen und Gewürze besonders gut aufnehmen. Das Verpackungsdesign stammt von der preisgekrönten Gestalterin Nikita Konkin. Merkmale: Öko Prüfziffer DE-Öko-006 Zutaten: Hartweizengrieß und Wasser Menge: 350 g Maße:

















































































































FREUDIGER GENUSS AUCH FÜR UNTERWEGS DA WIRD‘S EINEM WARM UMS HERZ 1 SANSIBAR GLÜHWEIN 1195 Ideal für heiße Getränke NEU Lieferung nur für den gewerblichen Bedarf. Alle Preise zzgl. MwSt.294 | WEIHNACHTEN 1 SANSIBAR GLÜHWEIN 0,75 Set, inklusive Becher und Lebkuchen 75 g Das Sylter Kultlokal gilt als Inbegriff für Lebensgefühl und Urgemütlichkeit. In diesem Jahr können Sie beides auch zu Hause genießen. Das Sansibar-Team sorgt mit dem eigens kreierten „Sansibar Sylt“ Glühwein (0,75 l, 8,6 % Vol.) für ganz besondere Genussmomente. Serviert wird der köstliche Tropfen im Porzellanbecher, der mit grauweißem Strickschal dekoriert ist. Dazu gibt es 75 g Lebkuchenallerlei, teilweise schokoliert. Maße: 9,8 x 8,7 x 12 cm 212 759 11,95 Inklusive Becher und Lebkuchen 2 „ELCH“THERMOBECHER 2 69 2 THERMOBECHER ELCH Auf den Elch gekommen! Ob Glühwein, Bowle, Tee oder Kakao, auf dem Weihnachtsmarkt oder beim Winterspaß, es soll heiß und fröhlich bleiben. Dieser doppelwandige Becher mit Schraubverschluss und verschließbarer Trinköffnung ist leicht zum Mitnehmen und macht Laune. Füllmenge: 400 ml Maße: Ø 8 x 17 cm 157 942 2,69 3 PUSTEFIX KLASSIK XMAS-EDITION mit 42 ml PUSTEFIX Auf der Weihnachtsfeier ein paar Seifenblasen in die Luft zu pusten ist ein Riesenspaß dem sich niemand entziehen kann! Mit dieser PUSTEFIX XMAS-Sonderedition ist Freude garantiert, denn der Weihnachtsmann macht mit! Füllmenge: 42 ml Maße: Ø 2,8 x 10 cm 226 878 -,99 3 PUSTEFIX XMAS-EDITIONKLASSIK 0 99 MADE GERMANYIN






















































































































































EXKLUSIVE BEFÜLLUNG NUR BEI UNS! 24 MAL EIN RIESIGES DANKESCHÖN FÜR GANZ BESONDEREMENSCHEN BESONDERE 295WEIHNACHTEN | 1 DANKESCHÖÖÖN ADVENTSKALENDER Sagen Sie doch einfach mal Dankeschööön! Und zwar ganz spektakulär mit einem riesigen Adventskalender im angesagten Pop Art Style. Auch die Füllung, die es so nur bei uns gibt, kann sich sehen lassen: Von weihnachtlichen Servietten, Funnyfrisch Chips, Räucherkerzen, Bonne Maman Konfitüre und einem Mars Riegel über Haribo Goldbären, Handcreme, Teekanne Früchtetee bis hin zu Lindor-Kugeln und vielem mehr. Maße: 39 x 45 x 14 cm 203 742 39,95 1 ADVENTSKALENDERDANKESCHÖÖÖN 39 95























































































KLEINE PRÄSENTE ERHALTEN DIE FREUNDSCHAFT 2 KALENDERMINI-ADVENTS15 95 NEU PRÄSENTKÖRBCHENWEIHNACHTS8 95 1 KÖRBCHENWEIHNACHTSPRÄSENT312 g Dieses Weihnachtspräsentkörbchen ist prall gefüllt mit Süßigkeiten. Hervorragend für Weihnachtsfeier, Zuhause, Büro, Restaurant, Café und Schaufensterdekoration geeignet. Ihre Kunden werden es lieben. : gesamt 312 g: 2x 10 g Haribo Merry Christmas, 3 x 8 g Schokoeier, 26 g Marzipanstick, 10 g SchokoSchneemann, 10 g Schoko-Bär, 40 g Schoko-Weihnachtsmann, 13 g Schokoglocke, 15 g Schoko-Zapfen, 3 x 5 g Schokotäfelchen, 3 x 10 g Eiskonfekt, 50 g Schokolinsen, 48 g Gelee- und Fondantkonfekt:22x17x 7 cm 224 350 8,95 3 TÄNNCHEN TO GO MARSHMALLOW 15 g Kleine Geste, große Nascherei! Die Marshmallow-Tannen sind perfekt als Mitbringsel oder um den Lieblingskollegen in der Weihnachtszeit mit einer kleinen Aufmerksamkeit zu überraschen. Maße: Verpackung 7 x 18 x 2 cm 204 212 -,99 3 TÄNNCHEN TO MARSHMALLOWGO 0 99 PRÄSENTKÖRBCHEN KÖRBCHEN Inhalt Fondantkonfekt Maße: 22 x 17 x Lieferung nur für den gewerblichen Bedarf. Alle Preise zzgl. MwSt.296 | WEIHNACHTEN 2 DER WOHL KLEINSTE ADVENTSKALENDER DER WELT Set / 16 Stk. Blister mit insgesamt jeweils 24 bunten Schokodragees, dazu eine bunt bedruckte Metallrückseite mit verschiedenen Weihnachtsmotiven – fertig ist der Adventskalender. Ihre kleinen Kunden werden jedem Tag entgegenfiebern an dem Sie wieder ein „Türchen“ öffnen dürfen. 16-er Set mit 2 verschiedenen Motiven im Polybeutel. 273 421 15,95






























































































MEHRFÜRGESCHENKEKREATIVENOCHFREUDE 297WEIHNACHTEN | 1 DAS IST DAS HAUS VOM NIKOLAUS Jetzt kommt das Haus vom Nikolaus direkt zu uns ins Büro oder nach Hause und macht uns selbst zum Nikolaus. Mütze und Bart herausnehmen und schon ist jede Menge Spaß garantiert. Ein tolles Geschenk auch für alle Mitarbeiter, wenn die Weihnachtsfeier nur online stattfinden kann. Für besonders lieb gewesenene Kinder und Erwachsene enthält das Haus auch eine Zuckerstange. Mit ganz viel Liebe in Werkstätten für Menschen mit Behinderung hergestellt. Maße: 9 x 9 x 16 cm 213 905 5,95 1 DAS IST DAS HAUS VOM NIKOLAUS 5 95 3 TOWEIHNACHTEN-GO 0 99 3 WEIHNACHTEN TO GO Unser „Weihnachten to go“ Tüten passen eigentlich immer: als kleine Aufmerksamkeit für Kunden als Mailing oder Giveaway oder als Überraschung für die Kollegen beim Zoom-Weihnachtsfest. Mit ganz viel Liebe in Werkstätten für Menschen mit Behinderung hergestellt. Füllmenge: 5-11 g Maße: 6 x 9 cm 213 868 liegtWeihnachtsduftinderLuft, 5 g -,99 213 876 Schneemann to go Marshmellow, 5 g -,99 213 884 Glühweingewürz, 5 g -,99 213 892 Glühwein to go, 11 g -,99 2 WEIHNACHTSMARKT HAUS Eine tolle Aufmerksamkeit für Firmen, die mit ihren Mitarbeitern keine Weihnachtsfeier machen können, als Einladung zu einem Weihnachtsmarktbesuch oder als ausgefallenes Geschenk: Mit dem Weihnachtsmarkt to go kommt auch zu Hause Stimmung auf. Das Haus enthält Glühweingewürz (5 g), ein lustiges Elchgeweih zum Umbinden, roten Traubensaft (200 ml) für Weihnachtspunsch und ein Weihnachtslied zum Singen. Mit ganz viel Liebe in Werkstätten für Menschen mit Behinderung hergestellt. Maße: 9 x 9 x 16 cm 213 913 5,95 2 WEIHNACHTS-MARKTHAUS 5 95 MADE GERMANYIN MADE GERMANYIN
































































































































































































































1 NÜSSCHENADVENTSKALENDER 2895 2 GEBÄCKTRUHE „ NOSTALGIE“ 13 95 Lieferung nur für den gewerblichen Bedarf. Alle Preise zzgl. MwSt.298 | WEIHNACHTEN 1 NÜSSCHENADVENTSKALENDER Für alle Nuss-Fans! Hinter jedem der 24 Boxen verstecken sich nussige Überraschungen: Ferrero Nutella, Giotto & Rafaello sowie Mandeln in Kakaohülle, in weißer Schokolade oder mit Zimtnote; dazu Erdnussbutter und KokosKrispy Döschen. So versüßen Sie die Adventszeit schon zum Frühstück. Maße: 47 x 50 x 33 cm 174 349 28,95 2 GEBÄCKTRUHE „NOSTALGIE“ gefüllt mit 450 g Gebäck Nostalgische Wintermotive zieren diese hochwertige Metalldose, deren Inhalt sich ebenfalls sehen lassen kann: 200 g Butterspekulatius, 125 g teilweise schokoliertes Lebkuchen-Allerlei und 125 g Vanillekipferl lassen keine Wünsche offen. Maße: 25 x 13,5 x 13 cm 193 278 13,95














































































ABER
9 95 3
1 RABBEL PRÄSENTDOSE „Ein Leben ohne Schokolade ist möglich aber sinnlos“ inkl. 125 g Pralinen Das Leben Ihrer Mitmenschen soll auf keinen Fall sinnlos werden. Darum empfehlen wir diese Präsentdose mit origineller 3D-Prägung, die mit ihren 125 g köstlichen Pralinen und Trüffel (ohne Alkohol) dem Leben garantiert einen Sinn gibt. Maße: 14,5 x 11 x 4,5 cm 163 627 9,95 PRÄSENTDOSE LEBEN OHNE SCHOKOLADE MÖGLICH SINNLOS MANCHMALPRÄSENTDOSEHILFTEBEN NUR NOCH SCHOKOLADE RABBEL PRÄSENTDOSE „Zauberhafte Weihnachten“ inkl. 125 g Pralinen Zauberhafte Weihnachten garantiert diese feine Selektion handgefertigter Pralinen und Trüffel (125 g /ohne Alkohol), die in der schwarzen 3D-Präsentdose mit Weihnachtsmannmotiv ein köstlicher Gruß sind. Maße: 14 x 11 x 5 cm 616 9,95 ZAUBERHAFTEPRÄSENTDOSEWEIHNACHTEN
2 RABBEL PRÄSENTDOSE „Manchmal hilft eben nur noch Schokolade“ inkl. 125 g Pralinen „Manchmal hilft nur noch Schokolade“ – das trifft auf diese Mischung kunstvoller, handgemachter Pralinés ganz sicher zu. Bereits die aufwendig gestaltete Metalldose macht Lust auf mehr. 125 g Pralinen und Trüffel (ohne Alkohol). Maße: 14 x 11 x 5 cm 137 424 9,95
EIN
185
9 95
1 RABBEL
MADE GERMANYINReliefs in 3D-Optik Reliefs in 3D-Optik Reliefs in 3D-Optik 299WEIHNACHTEN | PRÄSENTABEL UND DAZU NOCH UNGLAUBLICH LECKER UND VIELFÄLTIG
IST
9 95 2 RABBEL
3 RABBEL







































































36 x 41 cm ohne Henkel SP Spezialsiebdruck
naturfarbener Baumwolle, großes
Vorderseite
Fläche: 280 x 280 mm Preis/Stk.: ab 60
siehe Serviceseiten 017 958 ab 1,49 2 KAMINHOLZTASCHE Da passt ordentlich was rein. In dieser Kunstfilztasche ist Ihr Kaminholz bestens aufgehoben, nichts rieselt raus und der weiche Filz schont Teppiche und Böden. Material: Kunstfaser Maße: 50 x 26 x 26 cm 143 314 dunkelgrau 15,95 2 KAMINHOLZTASCHE 15 95 Lieferung nur für den gewerblichen Bedarf. Alle Preise zzgl. MwSt.300 | WEIHNACHTEN
Maße:
Motiv.
-,60
EIN SCHÖNES GESCHENK EIN SCHUTZENGELPERSÖNLICHERFÜRJEDEN IM12SET 3 INSCHUTZENGELTÜTEBUNT 12er-Set, 4-fach sortiert Sie vertreiben Kummer und Sorgen, trösten, schenken Liebe und Frieden – und sind damit eine besonders charmante Aufmerksamkeit für alle Menschen, die Ihnen am Herzen liegen. Jeder der unterschiedlich gestalteten Schutzengel aus Polyresin ist einzeln in einem Geschenktütchen verpackt, mit einem Originalgedicht einer berühmten Persönlichkeit. Maße: 4 cm 193 690 16,95 3 INSCHUTZENGELTÜTEBUNTDER 16 95 STÜCKAB STÜCK-PREIS 1.DRUCKFARBE 6012,452,15 -,60 250 1,95 -,38 500 1,75 -,35 1.000 1,65 -,30 2.000 1,49 -,30 Druckkosten weitere Farben: siehe Onlineshop 1 TASCHEEINKAUFSab 1 49
1 EINKAUFSTASCHE „FROHE WEIHNACHT“ mit weihnachtlichem Auf der Rückseite ist bedruck möglich. Einkaufstasche aus Fassungsvermögen. ca. auf Rückseite. Stück Werkzeugkosten:
Ihr eigener Wer-
mit 2 Henkeln































































































3 AUSWEIHNACHTSSCHLITTENFILZUNDHOLZ 7 95 NEU 301WEIHNACHTEN | 1 FILZ WEIHNACHTSMANNTASCHE 4 49 2 FILZ TANNENBAUMTASCHE 4 49 1 FILZ TASCHE WEIHNACHTSMANN inkl. 50 g Füllung Nicht nur hübsch anzusehen ist dieser süße Weihnachtsmann aus Filz. Einfach köstlich sind auch die Gaben, die er uns bringt: 1 Weihnachtsmann (12,5 g), 1 Weihnachtspraline im Dreheinschlag , 1 Weihnachts-Eiskonfekt-Täfelchen, 2 Zapfen mit Pralinenfüllung sowie 1 Vollmilch-Schokokugel mit Kakaocreme-Füllung. Maße: 14 x 9,5 x 5,5 cm 185 497 4,49 2 FILZ TASCHE TANNENBAUM inkl. 50 g Füllung Eine süße Aufmerksamkeit! Filztäschen in Form einer Tanne, gefüllt mit 50 g edlen Weihnachtspralinen aus Vollmilchschokolade mit Nougat- und Crispfüllung, dekoriert mit Schleife und Ringelband. Maße: 14 x 10,8 x 5,5 cm 185 510 4,49 3 WEIHNACHTSSCHLITTEN aus Filz und Holz Dieser süße Schneemann aus Filz hat seinen Holzkufen-Schlitten vollgeladen: mit 50 g Lebkuchen-Allerlei im Beutel dekoriert mit Schleife und Ringelband, einem Schneemann aus Vollmilchschokolade mit Milchcremefüllung (10 g), einem HARIBO Weihnachts-Fruchtgummi-Beutel, einer MANNER Neapolitaner Waffel (15 g), einem Marzipan-Brot (25 g) und einem Gelee-Barren. Maße: 11 x 8,5 x 15 cm 212 700 7,95














































































































































































TEILE5 PFLEGEULTIMATIVE 3 ENGELSEIFENSET 2 95 3 SEIFENSET ENGEL Inkl. Waschhandschuh, 2 Engel-Schafmilchseifen Engelsgleich: Dieses wunderschön verpackte Set, bestehend aus 2 wohlriechenden Schafmilchseifen (25 g) in Engelform und einem Waschhandschuh, ist das perfekte Weihnachtsgeschenk. Maße: 16 x 6,5 x 4 cm 224 180 2,95 NEU Lieferung nur für den gewerblichen Bedarf. Alle Preise zzgl. MwSt.302 | WEIHNACHTEN 1 BADESET WERKZEUGKOFFERIM 12 95 1 BADESET WERKZEUGKOFFERIM 5 Teile Körperpflege für „echte“ Kerle im originellen Werkzeugkoffer. Mit allem, was die beanspruchte Haut von Mann braucht: 100 ml Hair- & Bodywash und 100 ml reinigendes Peeling für besonders schmutzige Hände, eine Holz-Nagelbürste sowie ein Multi-Tool mit verschiedenen Werkzeugen. Natürlich stilecht mit charaktervoller Moschus-Note. 203 814 12,95 2 SEIFENSET WINTER SPA 2 95 2 SEIFENSET WINTER SPA Inkl. Waschhandschuh, 2 Tannenbaum-Schafmilchseifen Ein echtes Weihnachtsbonbon, das fertig verpackt mit Folie und Schleifen überreicht werden kann. Mit dem Waschhandschuh entfalten die 2 Tannenbäumchen aus Schafmilchseife (25 g) ihren Duft von Edeltanne und Zimtstern wohltuend auf der Haut. Maße: 16 x 6,5 x 4 cm 212 041 2,95

















































































































































Sparkle all the Way Dear Santa I love Christmas 303WEIHNACHTEN | 1 LADY SOCKS IN GESCHENKKUGEL je 2 Paar So aufregend haben Sie Socken noch nie verschenkt! Diese bunten Weihnachtssocken in drei unterschiedlichen Motiven sind in einer durchsichtigen Christbaumkugel aus Kunststoff verpackt und werden so schon bei der Übergabe zum absoluten Hingucker. Lady Socks aus 75 % Baumwolle, 20 % Polyester und 5 % Elasthan; waschbar bei 30°C. Größe: 36 – 41 „one size fits all“ Maße: ca. Ø 8,5 cm (Verpackung) 204 028 SparklealltheWay 5,95 204 036 Dear Santa 5,95 204 044 I love Christmas 5,95 1 LADY SOCKS IN GESCHENKKUGEL 5 95 3 RENTIERMOTIVWÄRMFLASCHE 4 99 3 WÄRMFLASCHE RENTIERMOTIV Ideal für kalte Winterabende und ein Klassiker der Hausapotheke. Mit ihrem gestrickten Bezug bleibt diese Wärmflasche aus Naturkautschuk noch länger warm und sorgt auch bei kleinen Wehwehchen für wohltuende Entspannung. Mit einem Herzanhänger für Ihre persönliche Grußbotschaft. Bezug: 100 % Acryl. Maße: 13,7 x 24,4 x 4,2 cm Füllmenge: ca. 600 ml 176 061 4,99 2 BIER DOSE MIT SOCKEN 4 99 2 BIER DOSE MIT SOCKEN 42-47 unisize Das erste Bier, dass man an den Füßen tragen kann. Garantiert alkoholfrei. Schon die Dosen-Verpackung wird Bier-Fans begeistern, innen befindet sich ein Paar stylische Socken mit Biermotiven, welche sortiert geliefert werden. Für Größe 42 bis 47. Maße: 13,5 x Ø 6,5 cm 213 921 4,99



























































































































































































































1 TOPMARKENWEIHNACHTENDANKESCHÖN-BOX 39 95 ÜBERRASCHENDE BOXEN SÜSSE BOTSCHAFTEN FÜR ALLE 1 WEIHNACHTENDANKESCHÖN-BOXTOPMARKEN Zur Weihnachtszeit ist ein Dankeschön der einfachste und beste Weg direkt ans Herz zu gehen und eine Botschaft der Anerkennung zu überbringen. Ob für Mitarbeiter oder Kunden, mit dieser Box der Superlative wird Ihr Dankeschön garantiert mit variieren.entgegengenommen.BegeisterungFüllungkann Inhalt: 2 x Mini Elisen, 50 g 1 x Mini Elisen glasiert, 50 g 3 x Lebkuchen glasiert, 25 g 3 x Lebkuchen Schoko, 25 g 1 x Feine 3-fachOblatenlebkuchen,sortiert,200g 1 x Contrella Lebkuchen, 200 g 1 x Lambertz Dominos dunkel, 175 g 1 x Lambertz Dominos weiß, 150 g 1 x Dominos braun, 150 g 6 x Schoko Ulmi, 21 g 2 x WEISS Cocosella, 100 g 1 x Schoko Printinchen, 200 g 1 x Mandel Honig Saftprinten, 100 g 206 322 39,95 3 LINDT GOLDBOX NO. 2 9 953 LINDT GOLDBOX NO. 2 Ein Gourmet-Christstollen (80 g), zwei zartschmelzende Lindor Kugeln (von Lindt, je 12,5 g) sowie ein leckerer Schoko-Weihnachtsmann (25 g) machen diese hochglänzende Präsentbox zu einem echten Goldschatz. Maße: 14 x 8,5 x 5,5 cm 144 171 9,95 2 CHOCRI WELTREISESCHOKOLADEN 165 g Verschenken Sie doch mal eine Weltreise! Wie? Ganz einfach: In dieser ansprechend gestalteten neuen Fenstersicht-Verpackung kann Ihr Kunde gleich sehen welche tollen 24 handbestreuten Schokotäfelchen ihn erwarten. Diese führen ihn in die Geschmackswelt dreier Kontinente. Das schmeckt nicht nur gut, das sieht auch so toll aus, dass das Produkt auf der Promotion World mit einem Messepreis für den besten Werbeartikel bedacht wurde. Maße: 20 x 20 x 3 cm (Verpackung) 151 744 11,95 2 WELTREISESCHOKOLADENCHOCRI 11 95 Lieferung nur für den gewerblichen Bedarf. Alle Preise zzgl. MwSt.304 | WEIHNACHTEN















































































































305WEIHNACHTEN | HERRLICH KNUSPRIG HERZHAFT ABWECHSLUNGSREICHEWEIHNACHTSZEIT 1 SNACK-ADVENTSKALENDER Schokolade und Gebäck sind was Feines – aber manchmal muss es einfach was Herzhaftes sein! Darum ist dieser Adventskalender „salzig“ gefüllt mit knusprigen funny-frisch Chips, POM-Bärs, Goldfischli, Piccos, Flippies & Co., jeweils in Portionsbeutel à 20-50g. So wird der Advent zur Snack- und Knabberzeit. Maße: ca. 39 x 46 x 14 cm 164 853 29,95 1 ADVENTSKALENDERSNACK29 95
















































































Merry VIELFÄLTIGEAUSWAHLENTDECKEN. FÜRMOTIVEJEDENANLASS!













































































































































































EntspanntE bEsinnlichE WEihnachtEn KARTEN FOTOKARTENUND SELBSTONLINEGESTALTEN KARTE AUSWÄHLEN BILDER HOCHLADEN TEXTE EINSETZEN UND NACH IHREN WÜNSCHEN KONFIGURIEREN PASSENDEN UMSCHLAG WÄHLEN MIT KARTENKONFIGURATORNEUEM www.hach.de/grusskarten















GANZ PERSÖNLICH UNIKATE MIT IHREM NAMEN hochwertige Geschenkbox aufEinzelnameMünzfach 1 LEDER-GELDBÖRSE INKL. 24LASERGRAVUR95 1 LEDER-GELDBÖRSE Inkl. Einzelnamengravur Außen glatt und schnörkellos – innen ein breit gefächertes Organisationstalent mit schwenkbarem Umklappfach. Diese braune Lederbörse besticht durch ihre edle, glatte Verarbeitung und ihre perfekte Aufteilung mit Münzfach, zwei Schein-Taschen, sechs Kreditkartenfächern, zwei Dokumentenfächern mit Netz sowie einem inneren Reißverschlussfach. Maße: 12 x 9,5 x 2,8 cm 127 278 24,95 Lieferung nur für den gewerblichen Bedarf. Alle Preise zzgl. MwSt.308 | GESCHENKE 2 SENATOR METALL-KUGELSCHREIBER SERIE „IMAGE“ im Lederetui inkl. Einzelnamengravur Hochwertige Schreibgeräteserie der deutschen Qualitäts-Marke Senator. Alle Schreiber bestechen durch eine kristallklare Linienführung, elegante Farben und ausgesuchte Materialien. Versehen mit einem Einzelnamen stellen Sie ein außer gewöhnliches Geschenk für jeden Empfänger dar. 117 004 chrom/mattschwarz 14,95 105 669 chrom 14,95 3 SENATOR METALL-SCHREIBSET SERIE „IMAGE“ in Geschenkbox, bestehend aus Kugelschreiber und Tintenroller, inkl. Einzelnamengravur 117 012 chrom/mattschwarz 25,95 105 677 chrom 25,95 Einzelname auf dem Schaft 3 SENATOR SCHREIBSETMETALLINKL. 25LASERGRAVUR95 2 SENATOR KUGELSCHREIBERMETALLINKL. 14LASERGRAVUR95
























































EIN PERSÖNLICHESGANZPRÄSENT 3-4 HAND- UND DUSCHTUCH VOSSEN VIENNA STYLE SUPERSOFT Ihre persönlichen Hand- & Duschtücher mit hochwertiger Stickerei verwöhnen Körper und Seele gleichermaßen mit. Vienna Style aus SUPERSOFT-Garn fühlt sich nicht nur einzigartig flauschig an, sondern ist vor allem auch super-saugfähig. Das ergibt ein Tuch, welches der Haut schmeichelt und ein wohltuendes Gefühl beim Abtrocknen hinterlässt. Der exklusive Vossen-Stick und die Ton-in-Ton-Stäbchenbordüre charakterisieren diese neuartige Symbiose aus Tradition und Moderne. Qualität: ca. 620 g/m². 100 % SUPERSOFT Baumwolle. 3 HANDTUCH VOSSEN 50 x 100 cm, Vienna Style Supersoft inkl. Einzelpersonalisierung 155 129 rot rubin 15,95 155 137 weiß 15,95 155 145 orange fiesta 15,95 155 153 grau pepplestone 15,95 191 061 deep blue 15,95 4 DUSCHTUCH VOSSEN 67 x 140 cm, Vienna Style Supersoft inkl. Einzelpersonalisierung 155 170 rot rubin 29,95 155 188 weiß 29,95 155 207 orange fiesta 29,95 155 215 grau pepplestone 29,95 191 070 deep blue 29,95 3 HANDTUCH VOSSEN VIENNA STYLE INKL.15STICKEREI95 2 BECHER „BAFY“ inkl. Einzelnamengravur Diese klassische Porzellantasse bietet Ihnen eine besonders effektvolle Veredelungsmöglichkeit: Dank Lasergravur erscheint ein individueller Name in der Farbe der Innenwände. Spülmaschinengeeignet. Inhalt: 350 ml 186 264 pink 9,95 186 272 rot 9,95 186 289 gelb 9,95 186 297 orange 9,95 186 301 grün 9,95 2 BECHER „BAFY“ INKL. LASERGRAVUR 9 95 Hochwertige Stickerei 1 MÜTZE MIT LED-LICHT, PER USB AUFLADBAR inkl. Einzelpersonalisierung Diese Mütze mit LED Licht wärmt nicht nur die Ohren, sondern bietet mit ihren drei Helligkeitsstufen zugleich mehr Sicherheit, Orientierung und Licht – etwa für Kinder auf dem Schulweg, beim Fahrradfahren oder Joggen. Bei Bedarf kann die LED-Beleuchtung ganz einfach herausgenommen und über den Computer wieder aufgeladen werden. Hinweise: 30 º waschbar. Einheitsgröße. 176 981 grau Einzelnamen-Stickereiinkl. 14,95 181 365 schwarz Einzelnamen-Stickereiinkl. 14,95 1 MÜTZE MIT LED-LICHT INKL. 14STICKEREI95 309GESCHENKE |














































































1 MANIKÜR-ETUI „ELAINE“ Maniküre macht Hände zum Hingucker! Ob zu Hause oder unterwegs – mit diesem 6-teiligen Maniküre-Set im eleganten Kunstlederetui sind Ihre Hände immer in den besten Händen. W Werbedruck. Fläche: ca. 35 x 30 mm Preis/Stk.: ab 50 Stück -,70 Werkzeugkosten: Siehe Serviceseiten. 141 288 schwarz ab 1,69 141 296 rot ab 1,69 STÜCKAB STÜCK-PREIS 1.DRUCKFARBE Druckkosten1.0001,695001,792501,991502,09502,2912,49weitereFarben: siehe Onlineshop 1 „ELAINE“MANIKÜR-ETUI ab 1 69 ES LEBE DER SPORT UND DANACH KOMMT DIEUNDENTSPANNUNGDANACHKOMMT ENTSPANNUNG
: ca. 13,7 x
3 MAXXMEE MINI MASSAGE GUN
Die „MAXXMEE“ Mini Massage Gun arbeitet mit bis zu 3.200 Schlägen pro Minute und liefert so eine kraftvolle Massage der Extraklasse ab. Die Durchblutung wird dabei intensiv angeregt. Im Set mit 4 leicht auswechselbaren Aufsätzen für nahezu jede Körperregion und Muskelgruppe. Mit den 4 Intensitätsstufen gegen Muskelkater, müde Beine & Co. passen Sie Ihr Massageerlebnis ganz Ihren Bedürfnissen an. Hochwertiges Aluminium-Gestell im modernen Design und kabelloser Akkubetrieb für maximalen Anwendungskomfort. Betriebszeit von bis zu ca. 6 Stunden bei voll aufgeladenem Akku. Mit Lithium-Ionen-Akku 3600 mAh. Praktisches Pocketformat, ideal für unterwegs. Maße 8,8
x 4,6 cm 214 586 59,3 MINIMAXXMEEMASSAGE GUN 59.verschiedene Aufsätze AufsatzGabelAufsatzKugelAufsatzPatronenAufsatzFlacherMANIKÜR-ETUI-,40-,50-,60-,65-,70 Lieferung nur für den gewerblichen Bedarf. Alle Preise zzgl. MwSt.310 | GESCHENKE 2 GELDBÖRSE NAPPALEDER Der Klassiker. Hochwertiges schwarzes Nappaleder. Gute Verarbeitung. Mit 6 Kreditkartenfächern. Klarsichtfach für Führerschein oder Personalausweis. Hartgeldfach mit Druckknopf-Verschluss sowie 3 Geldscheinfächer. Lieferung im Geschenkkarton. Maße: ca. 12 x 9 cm P Prägung. Fläche: ca. 50 x 20 mm Preis/Stk.: ab 15 Stück 2,20 Werkzeugkosten: Siehe Serviceseiten. 287 332 ab 6,95 STÜCKAB STÜCK-PREIS PRÄGUNG 1 8,45 15 8,10 2,20 30 7,95 1,95 100 7,45 1,50 250 6,95 -,95 2 NAPPALEDERGELDBÖRSE ab 6 95































































Außen glatt und schnörkellos – innen ein breit gefächertes Organisationstalent mit Umklappfach. Diese braune Lederbörse besticht durch ihre edle, glatte Verarbeitung und ihre perfekte Aufteilung mit Münzfach, zwei Scheintaschen, sechs Kreditkartenfächern, zwei Dokumentenfächern mit Netz sowie einem inneren Reißverschlussfach. Maße: 12 x 9,5 x 2,8 cm W Werbedruck. Fläche: 50 x 20 mm P Prägung. Fläche: 50 x 20 mm Preis/Stk.: ab 6 Stück Werkzeugkosten: Siehe Serviceseiten. STÜCK-PREIS PRÄGUNG
Druckkosten25010050206119,95–19,453,954,9518,953,204,2018,652,953,9517,952,503,5015,951,501,95weitereFarben:sieheOnlineshop
1.DRUCKFARBE
Werbeflächegroße1 COLLEGEMAPPEOFFICE-SET ab10 95TEILE4 3 LEDERGELDBÖRSE ab 15 95 311GESCHENKE | 2 POWERBANK„HIGHNESS“PORTFOLIOMIT5.000MAH ab 29 95 2 PORTFOLIO „HIGHNESS“ MIT 5.000 mAh POWERBANK Smarte DIN-A4-Dokumententasche mit eingebauter Powerbank. Innen mit großem Einsteckfach für Hefter und Unterlagen, kleinem Einsteckfach für Smartphone, Aufsteller, der in verschiedene Positionen gebracht werden kann – ideal für Präsentationen mit dem Handy oder Tablet –, elastische Fixierbänder zum Verstauen und Organisieren, diverse Einsteckfächer für Visitenkarten, Schlaufe für ein Schreibgerät, inklusive Schreibblock (DIN A4), mit umlaufendem Reißverschluss, außen ein großes Einsteckfach. Maße: 33,5 x 26 x 3 cm geschlossen L Laserbeschriftung. Fläche: auf Metallplättchen, 45 x 20 mm Preis/Stk: ab 3 Stück 8,50 Werkzeugkosten: Siehe Serviceseiten. 165 900 ab 29,95 STÜCKAB STÜCK-PREIS GRAVURLASER3142,9540,95 8,50 10 38,95 6,25 36,95 3,95 50 35,95 2,95 150 33,95 1,95 300 29,95 1,20 1 OFFICE-SET COLLEGEMAPPE Ein sensationelles Set zum Wahnsinnspreis. Ringbuchmappe mit Reißverschluss, A4, Einschubfach mit A4 Schreibblock, Einsteckfächer, elastische Schlaufe für Stifte, dehnbare Fächertasche. Material: schwarzes Kunstleder. 8-stelliger Taschenrechner. Telefon-/ Adressregister. Notizblock. Maße: ca. 34,5 x 28 x 3 cm W Werbedruck. Fläche: außen auf Mappe, ca. 80 x 40 mm Preis/Stk.: ab 8 Stück 3,95 Werkzeugkosten: Siehe Serviceseiten. 287 308 ab 10,95 STÜCKAB STÜCK-PREIS 1.DRUCKFARBE 8118,9517,95 3,95 50 16,95 1,95 250 15,95 1,45 500 13,95 -,95 1.000 10,95 -,90 Druckkosten weitere Farben: siehe Onlineshop 3 LEDERGELDBÖRSE
4,95
127 260 ab 15,95 STÜCKAB
















































































Drei gängige Messertypen, die in keiner Küche fehlen sollten! Schäl-, Allzweck sowie praktisches Santokumesser haben eine hohlgeschliffene Klinge mit korrosionsbeständiger Titanbeschichtung. Der geschwungene, den Konturen der Hand angepasste Soft-Grip Kunststoffgriff und ein kräftiger Knebel helfen, ein Abrutschen beim Arbeiten zu vermeiden. für den gewerblichen Bedarf. Alle Preise zzgl. MwSt.
Wenn das Brett voll ist, dann
Sie Schnittgut- und Schnittabfälle einfach in die zwei herausziehbaren Auffangschalen – und schon ist die Arbeitsfläche wieder sauber. Zugleich können Sie die Melaminschalen nicht nur zum Entfernen der Reste sondern auch zum Servieren verwenden. Maße: 35 x 25 x 5,5cm 140 523 19,95 4 SCHNEIDEBRETT MIT 2 AUFFANGSCHALEN 19 95 3 „THRILL4GRILL“GRILLZANGE ab 3 95 3 GRILLZANGE „THRILL4GRILL“ Diese XXL Grillzange aus robustem Edelstahl mit raffiniertem Arretierungsmechanismus packt alles und bewahrt den sicheren Abstand zur Feuerstelle. Maße: 44,5 x 5,5 x 3,8 cm L Lasergravur. Fläche: 160 x 8 mm Preis/Stk.: ab 30 Stück 1,40 Werkzeugkosten: Siehe Serviceseiten. 201 732 ab 3,95 STÜCKAB STÜCK-PREIS GRAVURLASER1 6,95 30 6,25 1,40 1005,95 1,20 250 5,45 1,5004,95 -,80 1.000 4,45 -,60 2.0003,95 -,40 1 VICTORINOX GESCHENKSET „CLASSIC“ ab 14 50 1 VICTORINOX GESCHENKSET „CLASSIC“ 3 Teile Seit 1884 steht der Name Victorinox für erstklassige Messer. In diesem Geschenkset mit frischen Farben an den Kunststoffgriffen. Maße: 27,5 x 11 x 2 cm W Werbedruck. Fläche: 60 x 20 mm auf Box Preis/Stk.: ab 7 Stück 3,Werkzeugkosten: Siehe Serviceseiten. 139 215 ab 14,50 SETAB PREISSET- 1.DRUCKFARBE 716,75116,95 3,1516,25 2,5015,90 1,50 10015,25 1,20 20014,50 -,95 Druckkosten weitere Farben: siehe Onlineshop
Arretierungsmechanismus TEILE3 FRISCH AUF DEN TISCH KOCHEN, SCHNEIDEN, GRILLEN WIE EIN PROFI 2 3ERINBROOKLYNKÜCHENMESSER-SETTITANIUMGESCHENKBOXSET
215 937 19,952 BROOKLYNKÜCHENMESSER-SETTITANIUM 19 95 TEILE3 Lieferung nur
312 | GESCHENKE 4 MITSCHNEIDEBRETT2AUFFANGSCHALEN
Dieses messerschonende Schneidebrett aus Bambus ist so, wie wir es uns schon immer gewünscht haben. schieben















































TEILE2 Designschuber TEILE4 313GESCHENKE | 1 METMAXX ChefDeBBQGRILLSET ab 9 95 3 TRANCHIERSET „ROASTY“ Edelstahl-Tranchierbesteck bestehend aus einem scharfen Fleischmesser, einer langen Fleischgabel, einer multifunktionalen Haushaltsschere und einem praktischen Kellnermesser. Das 4-teilige Set wird in einer schwarzen Nylon Tasche mit Schlaufe geliefert, wo Ihre Werbeanbringung perfekt präsentiert wird. Material: Edelstahl, Karbonstahl, Nylon Maße: ca. 36 x 9 x 2,7 cm SP Spezialdruck.. Fläche: ca. 180 x 40 mm Preis/Stk.: ab 12 Stück 3,50 Werkzeugkosten: Siehe Serviceseiten. 205 973 ab 6,95 SETAB PREISSET- 1.DRUCKFARBE 128,9519,95 3,50 308,65 3,20 807,95 2,50 1507,45 1,50 2506,95 -,95 Druckkosten weitere Farben: siehe Onlineshop 3 „ROASTY“TRANCHIERSET ab 6 95 2 SHOKUTSU MESSER Gefertigt in bester japanischer Handwerkstradition begeistert dieses extra scharfe Messer jeden Gourmetkoch. Handgeschmiedet aus feuergehärtetem 18/10 Stahl mit einem Griff aus Rosenholz. Ein weiteres Qualitätsmerkmal ist die wetzbare Klinge, die das Messer zu einem lebenslangen Begleiter macht. In feuergehärteter Holzbox im Designschuber. Maße: Box 35 x 7 x 4 cm L Lasergravur. Fläche: auf Griff 50 x 12 mm Preis/Stk.: ab 10 Stück 2,50 Werkzeugkosten: Siehe Serviceseiten. 197 484 ab 8,95 2 SHOKUTSU MESSER ab 8 95 STÜCKAB STÜCK-PREIS GRAVURLASER1011,95112,95 2,50 5010,95 2,1009,95 1,50 2509,45 1,20 5008,95 -,95 1 METMAXX ChefDeBBQGRILLSET Dieses extra scharfe Messer wurde in bester japanischer Handwerkstradition gefertigt. Handgeschmiedet aus feuergehärtetem 18/10 Stahl mit einem Griff aus Rosenholz. Ein weiteres Qualitätsmerkmal ist die wetzbare Klinge, die das Messer zu einem lebenslangen Begleiter macht. Praktisch ist die robuste, arretierbare Vollmetallzange zum Braten, Grillen und Wenden. Im stylischen Kartonschuber. Maße: Box 35 x 7 x 4 cm L Lasergravur. Fläche: 80 x 10 mm auf Preis/Stk.:Messergriffab10 Stück 2,95 Werkzeugkosten: Siehe Serviceseiten. 216 294 ab 9,95 STÜCKAB STÜCK-PREIS GRAVURLASER1014,45114,95 2,95 5013,95 2,10012,95 1,50 25011,95 1,20 5009,95 -,95


































































Lieferung nur für den gewerblichen Bedarf. Alle Preise zzgl. MwSt.
LOGITECHKABEL-MAUSM500S
Die innovative kabelgebundene Logitech® M500s Maus ermöglicht hyperschnelles Scrollen für erhöhte Produktivität. Mit dem fast reibungsfreien Scrollrad durchfliegen Sie lange Dokumente und Webseiten mit einer einzigen Bewegung. Oder wechseln Sie in den Präzisionsmodus, um von Zeile zu Zeile in Listen, Folien, Bildern und Menüs zu navigieren. Jetzt mit anpassbarer DPI-Einstellung (400–4000) für schnelle oder ultrapräzise CursorSteuerung. Weiche Seitenflächen und ein natürliches Design für mehr Halt und Kontrolle. Mit den sieben programmierbaren Tasten können Sie bequem in Webseiten und Fotoalben navigieren.
ist. Die kabelgebundene Tastatur einfach über USB verbinden und los geht‘s. Maße: 45 x 15,5 x 2,35 cm W Werbedruck. Fläche: auf Leertaste 50 x 10 mm Preis/Stk.: ab 10 Stück 17,95 Werkzeugkosten: Siehe Serviceseiten 215 082 grau ab 13,95 215 099 weiß ab 13,95 3 LOGITECHKABEL-MAUSM500S ab 29 95 1 BLUETOOTH MAUS LOGITECH PEBBLE M350 ab 19 95 2 BLUETOOTH TASTATUR LOGITECH K380 ab 39 95 4 LOGITECHKABEL-TASTATURK120 ab 13 95 STÜCKAB STÜCKPREIS 1.DRUCKFARBE 1 35,95 10 34,95 14,95 25 33,95 7,95 50 32,95 3,95 100 29,95 1,95 Druckkosten weitere Farben: siehe Onlineshop STÜCKAB STÜCKPREIS DIGITAL4C 1 44,95 10 43,45 4,95 2542,95 4,45 50 41,95 3,95 10039,95 2,95 STÜCKAB STÜCKPREIS DIGITAL4C 1 22,95 10 22,45 3,95 2521,95 3,45 50 20,95 3,25 10019,95 2,95 DRUCK4C DRUCK4C STÜCKAB STÜCKPREIS 1.DRUCKFARBE 1 15,95 10 15,45 17,95 25 14,95 9,95 50 14,45 6,95 100 13,95 4,95 Druckkosten weitere Farben: siehe Onlineshop
2 BLUETOOTH
Durch USB-Plug&Play ist die Maus sofort einsatzbereit. Maße: 6,9 x 12,6 x 4,2 cm W Werbedruck. Fläche: mittig unter „logitech“ 20 x 5mm Preis/Stk.: ab 10 Stück 14,95 Werkzeugkosten: Siehe Serviceseiten 214 981 grau ab 29,95 1 BLUETOOTH MAUS LOGITECH PEBBLE M350 Machen Sie mit der Logitech Pebble M350 – der mobilen Maus, die perfekt in Ihr Leben passt und Sie in allen Lebenslagen begleitet – jeden Arbeitsbereich minimalistisch, modern und geräuschlos. Die elegante organische Form passt in jede Tasche und liegt hervorragend in der Hand. Geräuschloses Klicken und Scrollen sorgen dafür, dass Sie in den Flow kommen können, ohne jemanden in Ihrer Umgebung zu stören. Maße: 5,9 x 10,7 x 2,65 cm D Digitaldruck. Fläche: mittig über „logi“ 25 x 10 mm Preis/Stk.: ab 10 Stück 3,95 Datenhandling: einmalig 29,214 990 graphit ab 19,95 215 007 grauweiß ab 19,95 215 015 rosa ab 19,95 215 023 eukalyptus ab 19,95 215 031 blaugrau ab 19,95 TASTATUR LOGITECH K380 Minimalistisch, modern und vielseitig an jedem Ort: die K380 Slim Multi-Device. Diese ultradünne und designorientierte Tastatur eignet sich perfekt zum Tippen am Computer, Smartphone, Tablet und mehr. Sie ist der ideale Helfer beim täglichen Multitasking. Maße: 27,9 x 12,4 x 1,6 cm D Digitaldruck. Fläche: auf Leertaste oben rechts 100 x 5 mm Preis/Stk.: ab 10 Stück 4,95 Datenhandling: einmalig 29,215 040 schwarz ab 39,95 215 066 grauweiß ab 39,95 215 074 rosa ab 39,95
314 | TECHNIK 3
4 LOGITECHKABEL-TASTATURK120 Aufgaben zu erledigen, sollte einfach sein, deshalb ist diese Tastatur in Standardgröße genau richtig. Sie ist ein zuverlässiger und strapazierfähiger Helfer mit Ziffernblock und benutzerfreundlichem Design, das sofort einsatzfähig


















2 BlueNanoSoundMETMAXXKOPFHÖRER ab 9 95 MitBeschichtungantibakterieller Inkl.AnschlußundUSB-LadekabelLadekabel Metallgehäuse 3 BLUETOOTH® LAUTSPRECHER „FREEDOM“ Dieser Lautsprecher macht aus dem Smartphone oder Tablet eine Musikanlage mit perfekter Klangqualität – und das ganz ohne Kabel. Verbinden Sie Ihre Geräte einfach per Bluetooth® mit dem Lautsprecher. Mit einer Reichweite von bis zu 10 Metern, einem Micro-SD-Slot und einer Laufzeit von bis zu 5 Stunden können Sie sogar überall Ihre Lieblingshits in bestem Sound anhören. Inklusive USB-Anschluss zum Aufladen. Material: (Gehäuse) Metall Maße: Ø 6 x 5 cm W Werbedruck. Fläche: 20 x 20 mm Preis/Stk.: ab 10 Stück 2,25 Werkzeugkosten: Siehe Serviceseiten. 171 733 blau ab 8,45 151 120 schwarz ab 8,45 158 236 silber ab 8,45 3 „FREEDOM“BLUETOOTH®LAUTSPRECHER ab 8 45 STÜCKAB STÜCK-PREIS DRUCKPREIS1.FARBE 1 10,95 10 10,45 2,25 50 9,95 1,45 200 8,95 -,85 500 8,45 -,60 Druckkosten weitere Farben: siehe Onlineshop 315TECHNIK | 1 BLUETOOTH LAUTSPRECHER JBL GO 3 JBL GO 3 sorgt für einen ausgefallenen Style und vollen JBL Pro Sound. Weil er wasser- und staubfest gemäß IP67 ist, bringt er Sie mit JBL Pro Sound bei jedem Wetter in Schwung. Dank der integrierten Trageschlaufe begleitet er Sie überall hin. GO 3 kommt in völlig neuen Farbtönen und Kombinationen, die von aktuellen Street Fashion Trends inspiriert sind. Maße: 8.8 x 7.5 x 4.1 cm D Digitaldruck 4c. Fläche: auf Rückseite 53 x 25 mm Preis/Stk.; ab 10 Stück 4,95 Datenhandling: einmalig 29,214 764 weiß ab 29,95 214 772 pink ab 29,95 214 789 blau ab 29,95 214 797 schwarz ab 29,95 214 828 rot ab 29,95 1 BLUETOOTH LAUTSPRECHER JBL GO 3 ab 29 95 DRUCK4C STÜCKAB STÜCKPREIS DIGITAL4C 1 34,95 10 33,95 4,95 25 32,95 4,45 50 31,95 3,95 100 29,95 2,95 2 METMAXX KOPFHÖRERBlueNanoSound Wireless TWS Hifi -Kopfhörer mit antibakterieller Beschichtung der Powerbankladebox für mehr Sicherheit und Gesundheit. 400 mAh Lithium-Polymer Akku für 3-5h Musik. Regulierbare Lautstärke. Maße: Ladebox 4,7 x 6 x 2,4 cm W Werbedruck. Fläche: 30 x 20 mm Preis/Stk.: ab 6 Stück 4,95 Werkzeugkosten: Siehe Serviceseiten. 214 326 schwarz ab 9,95 214 334 weiß ab 9,95 STÜCKAB STÜCKPREIS 1.DRUCKFARBE 1 18,95 6 17,95 4,95 12 16,95 3,85 25 15,95 3,55 50 14,95 2,55 100 13,95 1,95 250 12,95 1,25 500 9,95 -,85 Druckkosten weitere Farben: siehe Onlineshop



























































1 SONYON-EARKABELLOSEKOPFHÖRERWH-1000XM3 ab 179 95 SONYON-EARKABELLOSEKOPFHÖRERWH-CH510 ab 38 95
2
Für den Pendler und Genießer – Einfach mal abschalten und zurücklehnen mit Active Noise Cancelling und brillantem Klang. Genießen Sie kraftvollen Sound - egal wo Sie gerade sind. HIER OPTIKKLANGSTIMMENUNDÜBEREIN STÜCKAB STÜCKPREIS DIGITAL4C 101224,95219,95 4,95 25209,95 4,45 50 199,95 3,95 100179,95 2,95 STÜCKAB STÜCKPREIS DIGITAL4C 1 44,95 10 43,95 4,95 2542,95 4,45 50 39,95 3,95 10038,95 2,95 Lieferung nur für den gewerblichen Bedarf. Alle Preise zzgl. MwSt.316 | TECHNIK 1 KABELLOSE ON-EAR KOPFHÖRER SONY WH-1000 XM3 Aktives Noise Cancelling: Optimierung der Geräuschminimierung an Bewegungsmuster sowie Anpassung an den Luftdruck. Quick Attention Modus: blitzschnell die Umgebung durch intuitives Handauflegen wahrnehmen und Gestenkontrolle über Ohrmuschel zur Bedienung des Kopfhörers. Lange Akkulaufzeit: bis zu 30 Std. abhängig vom verwendeten Modus. Quick Charge: 10 Min. laden für 5 Std. Musik. Frequenzgang: 4 Hz - 40.000 Hz. Gewicht : 255 g D Digitaldruck. Fläche: auf der Ohrmuschel 50 x 20 mm Preis/Stk.: ab 10 Stück 4,95 Datenhandling: einmalig 29,214 957 schwarz ab 179,95 214 965 silber ab 179,95
2 KABELLOSE ON-EAR KOPFHÖRER SONY WH-CH 510 Kabellose Bluetooth Kopfhörer kraftvoller Klang, Quick Charge, bis zu 35 Stunden Akkulaufzeit, wireless. Schneller Zugriff per Sprache auf die Lieblingssongs und keine verpassten Benachrichtungen mehr Dank eingebautem Sprachassistent. Quick Charge: 10 Minuten Aufladen für 1, 5 Std Audiowiedergabe. Integrierte Headset-Funktion für handfreies Telefonieren. Gewicht : 132 g D Digitaldruck. Fläche: auf der Ohrmuschel 50 x 15 Preis/Stk.: ab 10 Stück 4,95 Datenhandling: einmalig 29,214 973 schwarz ab 38,95
DRUCKDRUCK4C4C







Tablets
BEWEGENDERSOUNDFÜRUNTERWEGS STÜCKAB STÜCKPREIS 1.DRUCKFARBE 1 39,95 10 38,95 14,95 25 36,95 8,95 50 35,95 5,95 100 33,95 4,95 Druckkosten weitere Farben: siehe Onlineshop STÜCKAB STÜCKPREIS DIGITAL4C 1 75,95 10 74,95 4,95 25 72,95 4,45 50 69,95 3,95 100 65,952,95 317TECHNIK | 1 JBLON-EARKABELLOSEKOPFHÖRERTUNE510BT
22 x 6,2 mm Preis/Stk.: ab 10 Stück 14,95
4,95 Datenhandling: einmalig 29,214 877 schwarz ab 65,95 1 JBLKOPFHÖRERON-EARKABELLOSETUNE500 BT ab 33 95 2 JBLON-EARKABELLOSEKOPFHÖRERTUNE600BTNC ab 65 95 DRUCK4C
Kabellose Lautsprecher und Kopfhörer sorgen für optimalen und ungestörten Hörgenuss – denn weit und breit ist kein Kabel in Sicht. Daher sind WirelessGeräte sowohl für ruhige als auch für sportliche Aktivitäten die perfekten Begleiter. Über die Bluetooth-Funktechnik empfangen diese ihre Ton-Signale kabellos von Smartphones, oder Computern – bis zu einer Reichweite von bis zu 30 Metern.
On-Ear-Kopfhörers im flach faltbaren, leichten und kompakten Design für alle Tage. Der JBL TUNE600BTNC mit den 32-mm-JBL-Treibern liefert den JBL Pure Bass Sound. Ein Sound, der ohne unnötiges Rauschen mehr als 12 Stunden kabellosen Musikgenuss bietet. Das zusätzliche abnehmbare Kabel ermöglicht im verkabelten Modus, mit oder ohne aktives NoiseCancelling, unendlichen Musikgenuss. In nur 2 Stunden ist der Kopfhörer vollständig wieder aufgeladen. Hergestellt aus langlebigen Materialien und in vier frischen Farben, der JBL TUNE600BTNC lässt sich schnell mit den Tasten an den Ohrmuscheln zwischen Telefonieren und Musikhören im Freisprechmodus umschalten Gewicht : 173 g D Digitaldruck. Fläche: auf dem Bügel 45 x 6,8 mm oder oberhalb der Ohrmuschel 22 6,2 Preis/Stk.: 10 Stück
x
:
Siehe Serviceseiten. 214 844 schwarz ab 33,95 214 852 weiß ab 33,95 214 869 blau ab 33,95 2
Mit dem JBL TUNE Der Bluetooth fähige JBL TUNE 510 BT Kopfhörer ist so benutzerfreundlich, dass man sich mit Siri oder Google Now verbinden kannst, ohne das Handy zu benutzen. Gewicht 155 g W Werbedruck. der Ohrmuschel Werkzeugkosten:
Fläche: oberhalb
JBLON-EARKABELLOSEKOPFHÖRERTUNE600BTNC
ab
510 BT Kopfhörer können Sie kraftvollen JBL Pure Bass Sound bis zu 40 Stunden Akkulaufzeit, ohne Kabel, ohne Wenn und Aber. Dieser Kopfhörer, der mit 32 mm Treibern von JBL und JBL Pure Bass Sound ausgestattet ist. Wenn Sie einen Anruf erhalten, während Sie auf einem anderen Gerät ein Video ansehen, wechselt der JBL TUNE 510 BT nahtlos zu Ihrem Mobilgerät.
mm














ENERGIEVOLLER Einfach Handy auflegen Ladestandanzeige Inkl. USB-Lade-kabel 1 „E-BAR“POWERBANK ab 2 95 DRUCK4C ENERGIE Lieferung nur für den gewerblichen Bedarf. Alle Preise zzgl. MwSt.318 | TECHNIKWEITERES SMARTPHONEZUBEHÖR FINDEN SIE IN UNSEREM ONLINESHOP! 3 „WIRELESSPOWERBANKPOWER“ Diese Powerbank mit eleganter, matter Metallic-Oberfläche zieht alle Blicke auf sich. Einfaches Auflegen auf die Kontaktfläche oder Laden per Kabel ist möglich. Inkl. USB-Kabel mit MicroUSB-Stecker (30 cm), Adapter für USB Typ C, integrierte Ladestandsanzeige und Ladefunktionsleuchte, Ein- und Ausschalter. Eingangsleistung: 5V/1A, Ausgangsleistung: 5V/1A (USB), 5V/1A (kabellos), Kapazität: 4.000 mAh. Maße: 12 x 7,5 x 1 cm W Werbedruck. Fläche: 40 x 30 mm Preis/Stk: ab 8 Stück 3,50 L Lasergravur. Fläche: 40 x 30 mm Preis/Stk: ab 8 Stück 3,95 Werkzeugkosten: Siehe Serviceseiten. 197 327 silber ab 10,95 197 335 schwarz ab 10,95 197 343 blau ab 10,95 197 351 rot ab 10,95 STÜCKAB STÜCK-PREIS 1.DRUCKFARBE GRAVURLASERDruckkosten500250100208115,95–14,953,503,9513,953,203,6513,451,952,9512,451,502,2010,95-,951,85weitereFarben:sieheOnlineshop3-in-1 Ladekabel 3 „WIRELESSPOWERBANKPOWER“ ab10 95 2 POWERBANK WEISS 10.000 mAh Mit dieser leistungsstarken Powerbank können bis zu zwei mobile Geräte gleichzeitig geladen werden. Mit digitaler LCD-Anzeige zur Anzeige der verfügbaren Kapazität. Zudem kann die Powerbank als Taschenlampe dienen. Inklusive USB Ladekabel. Output 1.0 A. und 2.1 A / 5V. Maße: 14 x 6 x 2,3 cm D Digitaldruck 4c. Fläche: 50 x 30 Preis/Stk.:mmab 6 Stück 5,Datenhandling: einmalig 29,177 904 ab 12,95 STÜCKAB STÜCK-PREIS DIGITAL4C 6118,9517,95 5,15 16,95 3,95 30 14,95 2,95 100 12,95 1,95 2 10.000POWERBANKmAh ab12 95 1 2.200POWERBANKmAh„E-BAR“ Unverzichtbar: eine leichte, geschmeidige aber effiziente Powerbank wie diese. Idealerweise im passenden Corporate Design. Seidenmatte ABS-Oberfläche. USB-/ Mikro-USB 5V Anschluss, inklusive Ladekabel. Maße: 9,5 x 2,5 x 2,5 cm Kapazität: 2.200 mAh W Werbedruck. Fläche: 75 x 15 mm Preis/Stk.: ab 25 Stück -,95 Werkzeugkosten: Siehe Serviceseiten. D Digitaldruck 4c. Fläche: 85 x 20 Preis/Stk.:mmab 25 Stück 1,50 Datenhandling: einmalig 29,165 967 dunkelblau ab 2,95 165 975 weiß ab 2,95 165 983 schwarz ab 2,95 165 991 rot ab 2,95 166 009 orange ab 2,95 STÜCKAB STÜCK-PREIS 1.DRUCKFARBE DIGITAL4C Druckkosten2.5001.0005001002515,95–4,95-,951,504,50-,801,253,95-,65-,953,50-,50-,852,95-,40-,60weitereFarben:sieheOnlineshop 20 POWERBANK 2.200 mAh „E-BAR“ inkl. Digitalruck 188 944 blau 188 952 weiß 188 969 rot 149.-WERBETIPP* DRUCK4C















































































2 USB STICK „SLIDE“ ab 2 95 1 POWERBANKALUMINIUMab 3 35 319TECHNIK | 2 USB STICK „SLIDE“ Die weiche Softtouch-Oberfläche macht diesen USB-Stick mit Kunstleder-Schlaufe zu einem echten Handschmeichler. Mit Schieberegler zum Ein- und Ausklappen. Die GEMA-Gebühren für USB-Sticks sind in unseren Verkaufspreisen enthalten und werden abgeführt. Maße: 5,7 x 2,2 x 1 cm W Werbedruck. Fläche: 40 x 12 mm Preis/Stk.: ab 20 Stück 1,95 Werkzeugkosten: Siehe Serviceseiten. 191 676 blau 4 GB ab 2,95 191 684 blau 16 GB ab 3,45 191 692 blau 32 GB ab 3,95 191 705 grün 4 GB ab 2,95 191 713 grün 16 GB ab 3,45 191 721 grün 32 GB ab 3,95 191 730 gelb 4 GB ab 2,95 191 748 gelb 16 GB ab 3,45 191 756 gelb 32 GB ab 3,95 191 764 rot 4 GB ab 2,95 191 772 rot 16 GB ab 3,45 191 789 rot 32 GB ab 3,95 191 797 schwarz 4 GB ab 2,95 191 801 schwarz 16 GB ab 3,45 191 810 schwarz 32 GB ab 3,95 191 828 weiß 4 GB ab 2,95 191 836 weiß 16 GB ab 3,45 191 844 weiß 32 GB ab 3,95 STÜCKAB PREIS4GB 16PREISGB 32PREISGB 1.DRUCKFARBE 1.0002,953,453,95-,755003,453,954,95-.952503,654,655,651,301004,155,156,151,65204,655,656,651,9514,955,956,95–DruckkostenweitereFarben:sieheOnlineshop 1 „ENDURANCE“ALUMINIUM-POWERBANK2.200mAh Die Ladestation für unterwegs! Mit der Powerbank können Sie Ihr Smartphone, Digitalkamera oder ein Tablet PC auch dann mit Strom versorgen, wenn keine Steckdose in der Nähe ist. Mit USB- und Mikro-USB-Anschluss, inklusive USB-Kabel. Maße: 9,5 x 2,2 x 2,2 cm Kapazität: 2.200 mAh W Werbedruck. Fläche: 60 x 13 mm Preis/Stk.: ab 25 Stück -,95 L Lasergravur. Fläche: 60 x 13 mm Preis/Stk.: ab 25 Stück 1,40 Werkzeugkosten: siehe Serviceseiten. 145 674 rot ab 3,55 145 666 hellblau ab 3,55 145 658 schwarz ab 3,55 145 640 silber ab 3,55 151 099 grün ab 3,55 179 615 dunkelblau ab 3,55 STÜCKAB STÜCK-PREIS 1.DRUCKFARBE GRAVURLASER1 4,75 25 4,20 -,95 1,40 100 3,95 -,60 1,20 250 3,75 -,55 -,85 500 3,65 -,50 -,75 1.000 3,55 -,35 -,60 Druckkosten weitere Farben: siehe Onlineshop














































































IHRZUMSCHLÜSSELKUNDEN Lieferung nur für den gewerblichen Bedarf. Alle Preise zzgl. MwSt.320 | TECHNIK 2 USB-STICK „SCHLÜSSEL“ Dieser USB-Stick ist ein echter Schlüssel zum Erfolg. Mit 8 oder 16 GB Speicherkapazität können Sie Ihr Unternehmen in all seinen Facetten präsentieren. Zugleich passt der USB-Stick mit Ihrem Firmenlogo als zusätzlicher Schlüssel an jeden Schlüsselbund. Maße: 5,7 x 2,4 x 0,3 cm Hinweis: Die GEMA-Gebühren für USB-Sticks sind in unseren Verkaufspreis enthalten und werden abgeführt. W Werbedruck. Fläche: 25 x 8 mm Preis/Stk.: ab 15 Stück 1,30 L Lasergravur. Fläche: 30 x 8 mm Preis/Stk.: ab 15 Stück 1,40 Werkzeugkosten: Siehe Serviceseiten. 126 613 blau 8 GB ab 3,95 126 621 rot 8 GB ab 3,95 126 630 schwarz 8 GB ab 3,95 126 890 silber 8 GB ab 3,95 167 913 blau 16 GB ab 4,45 167 921 rot 16 GB ab 4,45 167 930 schwarz 16 GB ab 4,45 167 948 silber 16 GB ab 4,45 1 USB-STICK ALU-DESIGN IN GESCHENKBOX USB-Stick in elegantem Alu-Design, praktisch und ein idealer Werbeträger. USB-Anschluß geschützt durch klappbaren Metallschieber. Hi-Speed USB (USB2.0). Kunststoffgeschenkbox mit Magnetschloss. Maße: Stick zusammengeklappt 5,5 x 1,5 x 0,8 cm Hinweis: Die GEMA-Gebühren für USB-Sticks sind in unseren Verkaufspreis enthalten und werden abgeführt. Lieferzeit mit Werbedruck ca. 3-4 Wochen. W Werbedruck. Fläche: Stick, 25 x 10 mm W Werbedruck. Fläche: Box, 60 x 20 mm Preis/Stk.: ab 15 Stück 1,50 Werkzeugkosten: Siehe Serviceseiten. D Digitaldruck 4c. Fläche: 25 x 10 mm Preis/Stk.: ab 15 Stück 2,50 Datenhandling: einmalig 29,081 561 schwarz 4 GB ab 3,25 090 208 schwarz 8 GB ab 3,45 162 675 schwarz 16 GB ab 3,95 081 553 blau 4 GB ab 3,25 090 216 blau 8 GB ab 3,45 164 079 blau 16 GB ab 3,95 105 853 rot 4 GB ab 3,25 105 861 rot 8 GB ab 3,45 164 087 rot 16 GB ab 3,95 1 USB-STICK ab 3 252 „SCHLÜSSEL“USB-STICK ab 3 95 STÜCKAB 4 GB8 GB 16GB 1.DRUCKFARBE DIGITAL4C 15,75 5,95 6,45 15 5,45 5,755,951,502,50 50 5,05 5,255,251,201,90 100 4,75 4,954,95-,751,50 300 4,55 4,754,75-,501,20 500 3,95 3,954,25-,45-,95 1.000 3,25 3,453,95-,40-,80 Druckkosten weitere Farben: siehe Onlineshop STÜCKAB 8 GB 16 GB 1.DRUCKFARBE GRAVURLASER1516,256,75–5,956,451,30 1,40 50 5,75 6,25 -,95 1,30 100 5,45 5,95 -,75 -,95 500 4,95 5,25 -,50 -,75 1.000 3,95 4,45 -,45 -,65 Druckkosten weitere Farben: siehe Onlineshop Gleich mitbestellen: GESCHENKBOX FÜR USB-SCHLÜSSEL Mit diesem hochwertigen Box wird aus dem USB-Stick „Schlüssel“ ein schönes Präsent für Ihre Maße:Kunden.9,5 x 4,5 x 2,2 cm W Werbedruck: auf Anfrage möglich 167 876 -,95 15 USB-STICK 4 GB 123 schwarz009 129.-WERBETIPP*
Pos.1+2:
Wegen der schwankenden EK-Preise bitten wir bei größeren Stückzahlen um Ihre konkrete Anfrage. Lieferzeit: bis 50 Stk. ab Lager, darüber ca. 2 Wochen.

























































1
INKL.MOUSEPAD4CWERBEDRUCK Dieses Mousepad können Sie nach Herzenslust bedrucken – vollflächig in 4c auf der Vorderseite. Vor allem Lasermäuse laufen auf der glatten Kunststoffoberfläche zu Hochform auf. Oberfläche aus kratzfester PräzisionsStrukturfolie (Hart-PVC ca. 400 μ), Druck direkt auf die Unterseite der Folie für brillante Wiedergabe. Frei von PAK nach EPA gem. ZEK-Empfehlung. Made in Germany. Maße: 190 x 230 mm Druckkosten für 4C-Werbedruck inklusive. W Werbedruck. Fläche: 190 x 230 mm Einmalige Werkzeugkosten: 55,141 583 Muster 3,50 141 591 inkl. 4C-Druck ab 2,95 MENGE INKL.STÜCKPREIS4CDRUCK 50 6,95 100 5,95 250 4,95 500 3,95 1.000 2,95 1 MOUSEPAD ab 2 95 Einhändig zu bedienen Inkl.Mikrofon Lichteffekte musikgesteuert 3 PARTYMR.METMAXXBOOMBASTICTOWERXL 29 95 3 METMAXX MR. BOOMBASTIC PARTY TOWER XL It’s party time! Ob zuhause oder unterwegs – die Boombox sorgt für den passenden Megasound (2x 5 Watt, Subwoofer). Und dank Mikrofon sind auch Ansagen & Gesangseinlagen möglich. Die Boombox verfügt über blue wireless 5.0, AUX und ein integriertes FM Radio. Die wiederaufladbare Batterie bietet ortsunabhängigen Musikgenuss für 2-5 Stunden. Inkl. praktischem Tragegurt. Maße: 41,5 x Ø 17,5 cm 215 904 29,95
* Komplettpreis inklusiv einfarbigem, einseitigen Werbeaufdruck in Standardschrift kratzfesteOberfläche 321TECHNIK | 2 POWERBANK „TOP ENERGY“ 4.000 mAh Diese Energiereserve für unterwegs ist ein echter Preis-Leistungs Hammer! Ob für Handy, Tablet oder Kamera – bei Bedarf können Sie Ihre Geräte auch ohne Steckdose mit dem nötigen Powerschub versorgen. Inklusive USBKabel mit Micro-USB-Stecker (Länge 30 cm). Eingangs- und Ausgangsleistung: 5 V/1 A, Leistung: 4.000 mAh. Maße: 9,7 x 4,5 x 2,3 cm W Werbedruck. Fläche: 60 x 10 mm oder 40 x 25 mm Preis/Stk.: ab 20 Stück 1,50 Werkzeugkosten: Siehe Serviceseiten. D Digitaldruck 4c. Fläche: 60 x 20 Preis/Stk.:mmab 20 Stück 2,95 Datenhandling: einmalig 29, 171 491 rot ab 4,25 171 506 weiß ab 4,25 171 514 blau ab 4,25 171 522 schwarz ab 4,25 STÜCKAB STÜCK-PREIS 1.DRUCKFARBE DIGITAL4C Druckkosten1.0005001002016,55––6,051,502,955,451,152,254,75-,851,954,25-,50-,95weitereFarben:sieheOnlineshop 2 „TOPPOWERBANKENERGY“ ab 4 25 DRUCK4C


























































WERBETIPP* 1 FFP2
Inkl. MaskenhalterInkl.Maskenhalter Perfekt für Sport und FreizeitKEINEHOHEFILTERNANOFASER-ATMUNGSAKTIVITÄTHAUTPROBLEME GERINGES GEWICHT FÜR DEN GANZEN TAG OHRBÄNDERELASTISCHEKOMFORTABLE WEITER NASENRÜCKEN 5-lagig Lieferung nur für den gewerblichen Bedarf. Alle Preise zzgl. MwSt.322 | GESUNDHEIT
als PSA (Persönliche
Einwegmo-
2 FFP2 SCHUTZMASKE selbstfi lternd, weiß Weiße Tensil FFP2-Schutz- und Sicherheitsmaske, selbstfilternd. 5 Schichten, heißversiegeltes Finish, Gummibänder. Formbare Nasenbügel für festen Sitz. Haken zur individuellen Kopfanpassung. Die Masken sind einzeln verpackt. Klassifiziert als PSA (Persönliche Schutzausrüstung) gemäß der Europäischen Norm EN 149:2001+A1:2009 mit CEKennzeichnung. Einwegmodell, nicht wiederverwendbar. Material: 43% Non-Woven, 28,5% Meltblown, 28,5% Baumwolle SP Fläche:Spezialsiebdruck. 60 x 40 mm auf linke Seite Preis/Stk.: ab 50 Stück -,95 D Digitaldruck 4c. Fläche: 60 x 40 mm auf linke Seite Preis/Stk.: ab 50 Stück -,95 Werkzeugkosten: Siehe Serviceseiten. 210 118 ab -,39 100 FFP2 SCHUTZMASKEN MIT WERBEDRUCKEINFARBIGEM 210 134 weiß 179.SCHUTZMASKE selbstfi lternd, farbig Tensil FFP2-Schutz- und Sicherheitsmaske, selbstfilternd. 5 Schichten, heißversiegeltes Finish, Gummibänder. Formbare Nasenbügel für festen Sitz. Haken zur individuellen Kopfanpassung. Klassifiziert Schutzausrüstung) päischen mit CE-Kennzeichnung. dell, nicht wiederverwendbar. 43% Non-Woven, 28,5% Meltblown, 28,5% Baumwolle Fläche:Spezialsiebdruck.
Material:
60 x 40 mm auf linke Seite Preis/Stk.: ab 50 Stück -,95 D Digitaldruck 4c. Fläche: 60 x 40 mm auf linke Seite Preis/Stk.: ab 50 Stück 3,15 Werkzeugkosten: Siehe Serviceseiten. 210 011 blau ab -,49 210 020 grau ab -,49 210 003 pink ab -,49 210 038 schwarz ab -,49 STÜCKAB STÜCK-PREIS 1.DRUCKFARBE DIGITAL4C 1-,99–50 -,89 -,95 3,15 100-,79 -,85 2,95 250 -,69 -,75 2,55 500-,65 -,70 2,35 1.000 -,59 -,65 2,15 2.500-,55 -,60 1,95 5.000 -,49 -,50 1,69 Druckkosten weitere Farben: siehe Onlineshop 1 FFP2 SELBSTFILTERND,SCHUTZMASKEFARBIG ab 0 49 5-lagig 2 FFP2 SELBSTFILTERND,SCHUTZMASKEWEISS ab 0 39 STÜCKAB STÜCK-PREIS 1.DRUCKFARBE DIGITAL4C 1 -,65 50 -,56 -,95 3,15 100 -,54-,85 2,95 250 -,52 -,75 2,55 500 -,49-,70 2,35 1.000 -,46 -,65 2,15 2.500 -,44-,60 1,95 5.000 -,39 -,50 1,69 Druckkosten weitere Farben: siehe Onlineshop 3 FFP2 SCHUTZMASKE AIR QUEEN BREEZE, nur 3,71 g Die Air QUEEN Breeze Maske kann durch ihre einzigartige Membranfaser Hitze und Feuchtigkeit optimal filtern. Die Nanomembran hat eine ausgezeichnete Luftdurchlässigkeit und behält auch bei Kontakt mit Feuchtigkeit mehr als 24 Stunden lang 80 % ihrer Leistung. Material: Vlies Zertifi zierung: EN 149:2001+A1:2009 CE 2163 DT Digitaldruck Transfer Fläche: 60 x 35 mm auf linke Seite Preis/Stk.: ab 50 Stück -,99 Werkzeugkosten: Siehe Serviceseiten. 211 715 weiß 1,49 3 FFP2 SCHUTZMASKE AIR QUEEN BREEZE 1 49 DRUCKDRUCK4C4C DRUCK4C
SP
Die Masken sind einzeln verpackt.
gemäß der Euro-
Norm EN 149:2001+A1:2009















































MADE GERMANYIN 3-Lagig 323GESUNDHEIT |* Komplettpreis inklusiv einfarbigem, einseitigen Werbeaufdruck in Standardschrift VERARBEITETEHOCHWERTIGMASKENMADEINGERMANY 2 FFP2 MASKE „COLOUR“ Made in Germany • Hervorragende Atemeigenschaften bei hoher Filterleistung durch den Einsatz hochwertiger Vlies-Stoffe. • Sicherer und wirksamer Schutz vor Partikeln, flüssigen und festen Aerosolen für den Träger und sein Gegenüber. • Hochwertig verarbeitete Maske mit 5 schützenden Schichten. Frei von Glasfaser, Latex und Gerüchen. • Extra hautfreundliches Vlies mit sehr geringen Atemwiderständen, hoher Tragekomfort und eine hervorragende Passform. Material: Spinnvlies, Meltblown. Zertifi zierung: CE 2233 EN 149:2001 + A1:2009. Maße: 17,5 x 9,5 cm SP Spezialsiebdruck. Fläche: auf rechte Seite 60 x 40 mm Preis/Stk.: ab 50 Stück -,95 DT Digitaldruck Transfer. Fläche: auf rechte Seite 60 x 40 mm Preis/Stk.: ab 50 Stück 1,49 Werkzeugkosten: Siehe Serviceseiten. 220 236 schwarz ab -,99 220 244 hellgrün ab -,99 220 252 dunkelgrün ab -,99 220 269 pink ab -,99 220 277 orange ab -,99 220 285 hellblau ab -,99 220 293 dunkelblau ab -,99 220 308 rot ab -,99 STÜCKAB STÜCK-PREIS 1.DRUCKFARBE DIGITAL4C 1 1,95 50 1,65 -,95 1,49 100 1,55 -,85 1,29 250 1,45 -,75 1,19 500 1,35 -,70 1,09 1.000 1,25 -,65 -,99 2.500 1,15 -,60 -,89 5.000 1,05 -,50 -,79 10.000 -,99 -,40-,69 Druckkosten weitere Farben: siehe Onlineshop 2 FFP2 „COLOUR“MASKE ab 0 99 1 ZERTIFIZIERTE OP GESICHTSMASKEN TYP II SET / 50 STK. Bei dieser OP-Maske handelt es sich um eine 3-lagige Mund- und Nasenmaske für den Alltagsgebrauch. Äußere Schicht aus Vlies und Filterpapier, innere Schicht aus hautfreundlichem Vlies. Atmungsaktiv und bequem dank geringem Atemwiderstand. Mit dem Nasenbügel ist sie gut geeignet für alle Gesichtsformen. Das Set beinhaltet 50 Stück Gesichtsmasken. Besonderheiten: Zertifiziert nach EN14683:2019 Typ II Material: Vlies Maße: Box 18 x 10 x 7 cm, Maske 17 x 9 cm 210 142 blau 5,95 220 880 schwarz 5,95 220 898 pink 5,95 OP-GESI50CHTS-MASKEN595















































































































































•
• Erkennt
PREISTAGESAKTUELLERONLINE! mit Papierhalterfür Teströhrchen Lieferung nur für den gewerblichen Bedarf. Alle Preise zzgl. MwSt.324 | GESUNDHEIT 1 HOTGEN LAIENTEST NOVEL SARS-COV2 ANTIGEN TEST einzeln verpackt Dieser Laientest wird für die qualitative Bestimmung von Coronavirus-Antigen in menschlichen Nasen- oder Rachenabstrichen verwendet. Er dient zur schnellen Untersuchung von Verdachtsfällen auf neuartige Coronaviren. Der Test wird einzeln verpackt in einer Einzelkartonage mit deutschsprachiger Anleitung geliefert. Die Anwendung durch den Laien (Selbstest) wurde durch das BfArM freigegeben. Einfache Handhabung, keine zusätzlichen Materialien notwendig. Test für den privaten Gebrauch zugelassen. Besonderheiten: • Sensitivität: 95,37 % • Spezifität: 99,13 % • Für den Gebrauchprivatenzugelassen • Entnahme von Nasenabstrich • 1 Test in einer Einzelkartonage • deutschsprachige Anleitung • Ergebnisse nach 15 Minuten 211 217 Preis auf Anfrage ErgebnisSchnellesinnur15 Minuten MIT LAIEN-SELBSTTEST FÜR MEHR SICHERHEIT UND FREIHEIT 15 MIN 2 GREEN SPRING COVID19 ANTIGENTEST LOLLI, NASAL ODER RACHEN
• Trotz geringer
•
gute
Besonderheiten: BfArM gelistet: AT417/20 PZN: 17394138 Sensitivität: 98,00 % Spezifität: 100 % Test erfolgt mittels Speichelprobe oder Nasal 25 Testkassette auch die Omikron Variante Virenlast Ergebnisse
Der Antigen Schnelltest kann anders als ein Antikörper Test den Erreger von COVID-19, den Coronavirus SARSCoV-2, direkt nachweisen. Dabei weist er die Proteine des Virus (die Antigene) nach. Diese sind in Speichelproben oder im vorderen Nasenbereich anzufinden, wenn sich der Virus dort repliziert. Der Antigen Schnelltest ist somit ähnlich wie der PCR-Test insbesondere in der Anfangsphase der Infektion sensitiv. Dabei kann er auch ähnlich wie der PCR-Test eine Virusinfektion anzeigen, bevor Symptome auftreten. Er schlägt auch bei geringer Virenlast an und Liefert gute Ergebnisse.
•
•
•
x
• Verwendung nur durch medizinisch geschultes Personal 221 010 39,15 MIN 2 GREEN SPRING COVID19 ANTIGENTEST LOLLI, NASAL ODER RACHEN 39.STÜCK25
•























































































































































































Hinweis: Sonderzulassung beim Bundesinstitut für Arzneimittel und Medizinprodukte (BFARM) - BfArM Aktenzeichen 5640-S-025/21 Besonderheiten: Sensitivität: 86,4 % 99,6
•
Der Roche Antigen Selbsttest dient zuverlässig und schnell Menschen mit Verdacht auf SARS-CoV-2 zu erkennen. Das Ergebnis liegt innerhalb von 15 Minuten vor. So ist eine schnelle Identifikation von Infizierten möglich. Mit diesem Schnell-Test kann ein genaues Screening von Personen mit bekanntem Kontakt zu SARS-CoV-2-Infizierten durchgeführt werden. Zusätzlich liefert er schnelle Antworten hinsichtlich des Infektionsstatus. Die Anwendung ist für Laien unkompliziert, wo immer das Testkit benötigt wird - ortsunabhängig und effizient sofort einsatzbereit.
• Spezifität:
SCHNELL ZUM ERGEBNIS nurTestergebnisin15Minuten Bequemer Abstrich im vorderen NasenbereichBequemer Abstrich im vorderen Nasenbereich 325GESUNDHEIT | 1 SIEMENS CLINITEST RAPID COVID-19 ANTIGEN LAIENTEST 79.2 ROCHE SARS COV-2 ANTIGEN TEST - SONDERZULASSUNG LAIENTEST 149.1 SIEMENS CLINITEST RAPID COVID-19 ANTIGEN LAIENTEST 20 Stück Der Clinitest Rapid COVID-19 Antigen Test von Siemens weist eine akute COVID-19 Infektion innerhalb von 15 Minuten am Point-of-Care schnell und zuverlässig nach. Im Vergleich zu anderen Corona-Tests ist ein vorderer Nasenabstrich zu entnehmen. Nasen-Abstrichproben von Personen unter 18 Jahren sollten unter Aufsicht von Erwachsenen durchgeführt werden. Personen über 70 Jahren sollten sich bei der Entnahme ihres Nasen-Abstrichs unterstützen lassen. Besonderheiten: • Sensitivität: 97,25 % • Spezifität: 100 % 202 436 79,2 ROCHE SARS COV-2 ANTIGEN TEST - SONDERZULASSUNG LAIENTEST, 25 Stück
% 211 194 149,STÜCK20 COVID-19 TESTS KÖNNEN TAGESABHÄNGIGEN PREISÄNDERUNGEN UNTERLIEGEN!




















































Die Livinguard Fitness Maske ist
LIVINGUARD
MITGESICHTSMASKEFITNESS-ANTI-VIRUS-TECHNOLOGIE
Das mit Livinguard Technologie behandelte Gewebe inaktiviert nachweislich bis zu 99.9% alle SARS-2 (CoVid-19) Erreger. Dieser Schutz bleibt auch nach mehrmaligem Tragen und Waschen erhalten. Einkaufswagen Waschbar wiederverwendbarundEliminiertwirksambiszu99,9%desSars-Cov-2Virus2 GESICHTSMASKELIVINGUARD „PRO“ MIT ANTI-VIRUS-TECHNOLOGIE 19 95 3 LIVINGUARD MITGESICHTSMASKEFITNESS-ANTI-VIRUS-TECHNOLOGIE 24 95 Touchscreen-kompatibel HIGHTECH Hightech-Inaktivator gegen Viren und Bakterien ATMUNGSAKTIVITÄTOPTIMALE 5x besser als Baumwolle HÖCHSTER KOMFORT ElastizitätNatürliche REVOLUTIONÄRE MASKE VONINAKTIVIERUNGVIREN InklusivepraktischerTasche Jetzt auch mit Ihrem Logo Lieferung nur für den gewerblichen Bedarf. Alle Preise zzgl. MwSt.326 | GESUNDHEIT 1 LIVINGUARD HANDSCHUHE „STREET GLOVE“ MIT VIRUS-TECHNOLOGIEANTIEin Handschuh der das anfassen wieder sicher macht. 95% Baumwolle und 5% Elastan sorgen für Atmungsaktivität und Haltbarkeit. Touchscreen kompatibel und schmutzabweisend, „Street Glove“ kann bis zu 30x gewaschen werden ohne Verlust der Wirksamkeit. 210Damengröße159 Größe S 9,95 210 167 Größe M 9,95 210 175 Größe L 9,95 210Herrengröße183 Größe M 9,95 210 191 Größe L 9,95 210 206 Größe XL 9,95 2 LIVINGUARD GESICHTSMASKE „PRO“ MIT TECHNLOGIEANTI-VIRUSDurch die revolutionäre und patentierte Technologie zur Inaktivierung von Viren schützt die Livinguard Maske bedeutend besser als herkömmliche Masken. Die Livinguard-Maske kann bis zu 30 Mal gewaschen werden, ohne ihre schützende Wirkung zu verlieren. Der seidenweiche, geruchsneutrale Stoff sowie die verstellbaren Ohrschlaufen und der anpassbare Nasebügel gewährleisten eine individuelle Passform mit höchstem Komfort. Die Maske kann vor dem Waschen mehrmals wiederverwendet werden, da der High-Tech Stoff Mikroorganismen kontinuierlich zerstört. Klassifiziert als Medizinprodukt der Risikoklasse 1 und somit für ÖPNV geeignet. Zertifi zierung: EN 14683:2019 Typ 1 Maße: M (14 x 17cm), L (15 x 18cm) SP Siebdruck. Fläche: 40 x 30 mm Preis/Stk.: ab 4 Stück 7,50 Werkzeugkosten: einmalig 45,210 079 Größe L 19,95 210 062 Größe M 19,95 3
für den täglichen aktiven Gebrauch gefertigt. Schnell trocknend mit natürlichem Stretch und verstellbarem Kopfband, dass die Tragbarkeit revolutioniert. Fortschrittliche Lyocell-Mikrofaser mit 5-mal höherer Atmungsaktivität als StandardBaumwollgewebe. Größenverstellbarer Klettverschluss. Die Maske kann bis zu 150 x mit kaltem Wasser gewaschen werden. Zertifi zierung: EN 14683:2019 Typ 1 Maße: M (14 x 17cm), L (15 x 18cm) SP Siebdruck. Fläche: 40 x 30 mm Preis/Stk.: ab 4 Stück 7,50 Werkzeugkosten: einmalig 45,210 095 Größe L 24,95 210 087 Größe M 24,95 1 LIVINGUARD HANDSCHUHE „STREET GLOVE“ MIT ANTIVIRUS-TECHNOLOGIE 9 95






























KONTAKTLOSMESSEN SAUBERE & GESUNDE RAUMLUFT AustauschbarerFilter 327GESUNDHEIT | 1 FIEBER-THERMOMETER Mit diesem Thermometer können Sie einfach und schnell die Körpertemperatur von Personen oder die Oberflächentemperatur von Materialien messen. Die Bedienung ist denkbar einfach: Das Thermometer wird mit einem Abstand von 5 bis 15cm auf die Stirn gerichtet und anschließend die Messtaste betätigt – schnell und hygienisch unbedenklich, da komplett kontaktfrei gemessen wird. Merkmale: Messdauer: < 0,5 Sekunden, Grenzwertalarm mit akustischem Signal, großes Display zur gleichzeitigen Darstellung von Messwert und Speicherwerten, Hintergrundbeleuchtung, Genauigkeit ±0,3°C (30...40°C), Messwertspeicher für 32 Messungen, Batteriebetrieb über 2x AA im Lieferumfang nicht enthalten Maße: 4,6 x 7 x 13 cm 210 214 49,Bitte gleich mitbestellen: PANASONIC ALKALI-BATTERIEN „EXTREME POWER“ MICRO „AA“, SET / 4 STK. 285 079 2,59 1 FIEBER-THERMOMETER 49.2 AIR CARE 1000 VIRUS EX H14 ION Ob am Arbeitsplatz oder zu Hause: Der Air Care Luftfilter sorgt für reine Luft und verringert das Infektionsrisiko! Aerosole gelten als Hauptüberträger des SARS-CoV-2-Erregers – dank H14 HEPA-Filter filtert dieser leistungsstarke Luftreiniger 99,995 % der Aerosole aus der Raumluft. Ein integrierter Ionisator wirkt staub- und aerosolbindend sowie keimtötend auf Viren und Bakterien, außerdem werden Gerüche neutralisiert. Zugleich schützt der Luftfilter vor Schimmelpilzsporen, Pollen, Hausstaubmilben. Dank Vorfilter werden auch grobe Schmutzpartikel und Tierhaare gefiltert. Pro Luftfilter können ca. 125 m3/h Luft umgewälzt werden (etwa 10-13 qm), bei größeren Räumen können mehrere Geräte problemlos miteinander kombiniert werden. Mit drei Ventilationsstufen, Aromabox für ätherische Öle sowie Indikator für den Filterwechsel. VORTEILE AUF EINEN BLICK: • Sofort losEinstecken,einsatzbereit!anschalten,geht’s + Mehr derFiltertSicherheit!99,995%angesaugten Viren • Integrierter Indikator für Filterwechsel • Ein Gerät je 10-13 m² empfohlen • 3 Ventilationsstufen + Aromabox für ätherische Öle • Luftumwälzung ca. 125 m³/h: • 4 in 1 Luftreinigung: Vorfilter, H14 Aktivkohlefilter,HEPA-Filter, Ionisator • absorbiert Chemikalien, Gase und Geruchsstoffeunangenehmeausder Luft Gewicht: 2,49 kg Maße: 21,1 x 27,6 x 21, 4 cm 211 516 199,Gleich mitbestellen: 211 653 Ersatzfilter 79,2 AIR CARE 1000 VIRUS EX H14 ION 199.Kontaklose Messung
































212
1.000
Lieferung nur für den gewerblichen Bedarf. Alle Preise zzgl. MwSt.328 | GESUNDHEIT
212
2 IMPFPASSHÜLLE
5.000 -,60 -,15 10.000 -,55 -,13 Druckkosten weitere Farben: siehe Onlineshop 2 IMPFPASSHÜLLE ab0 55 MADE GERMANYIN Individuelle Werbeanbringung in schwarz gestaltbarkomplettUmverpackungin4C DRUCK4C 1 FÜRANTIBESCHLAGTUCHBRILLENTRÄGER Beste Aussichten für Brillenträger endlich auch mit Maske. Dank der speMadeimständigenindividuellewiederverwendetkungen.MaskeKochen,8sorgtziellenAntibeschlag-ImprägnierungdiesesMicrofasertuchbiszuStundenfürklareSicht–obbeimSport,beimTrageneineroderbeiTemperaturschwan-DasTuchkannbiszu140malwerden,sodassIhreWerbebedruckungzumBegleiterwird.LieferungwiederverwendbarenPolybeutel.inGermany. Besonderheiten: • hochwertiger 4c-Werbedruck • individuelle Einzelverpackung • bis zu 8 Stunden klare Sicht Maße: 17 x 14 cm Muster: 211 250 5,95 W Werbedruck 1c auf Tuch. Fläche: 56 x 32 mm D Digitaldruck 4c auf Verpackung 210 505 ab 2,95 STÜCKAB INKL.STÜCKPREISDRUCK 250 4,45 500 3,95 1.000 3,45 2.500 2,95 1 FÜRANTIBESCHLAGTUCHBRILLENTRÄGER ab 2 95
200
Die Schutzhülle ist in fünf verschiedenen Farben erhältlich. Maße: Universal: offen 215 x 150 mm Kompakt: offen 200 x 135 mm W Werbedruck. Fläche: 70 x 50 mm Preis/Stk.: ab 200 Stück -,18 Werkzeugkosten: siehe Serviceseiten. Universal (für internationale gelbe Impfausweise vor 1970 bis heute) 880 transp. ab -,55 212 898 schwarz ab -,55 212 902 weiss ab -,55 212 919 rot ab -,55 212 927 blau ab -,55 Kompakt (für aktuelle Impfausweise seit 2005) 839 transp. ab -,55 847 schwarz ab -,55 855 weiss ab -,55 863 rot ab -,55 212 871 blau ab -,55 -,95 -,85 -,18 500 -,75 -,17 -,70 -,16
Der Impfpass wird zum wichtigen Begleiter, um die Vorzüge der Lockerungen genießen zu können. Bedruckbare und personalisierte Impfausweishüllen schützen das wichtige Dokument zuverlässig und lassen sich mit einem Firmenlogo veredeln. So erhalten Sie ein besonders langlebiges Werbemittel mit hohem Aufmerksamkeitspotential.
212
212
212
STÜCKAB STÜCK-PREIS 1.DRUCKFARBE 1
































































































Siehe Serviceseiten. 120 580 blau -,39 120 598 rot -,39 4 BROTDOSE „FRESH“ Ob Brote, Obst, Gemüse oder andere Leckereien – mit diesen zweifarbigen Brotdosen wird die Frühstückspause garantiert köstlich und Ihre Werbebotschaft zum täglichen Begleiter. Maße: 17,5 x 7 x 14 cm W Werbedruck. Fläche: 135 x 75 Preis/Stk.:mmab 25 Stück 1,20 Werkzeugkosten: Siehe Serviceseiten. D Digitaldruck 4c. Fläche: 140 x 90 Preis/Stk.:mmab 25 Stück 2,60 Datenhandling: einmalig 29,183 713 blau 2,45 183 721 rot 2,45 183 730 grün 2,45 329SALES | 1 60 JETZTNUR 079 2 15 JETZTNUR 089 4 25 JETZTNUR 199 0 49 JETZTNUR 029525 JETZTNUR 245 0 75 JETZTNUR 039
5 FILZ-LANYARD „STATEMENT“ Diese kultigen Schlüsselbänder in Filzoptik bieten besten Platz für ein individuelles Statement und sind auch mit Ihrem Firmenlogo oder Slogan ein Hingucker. Maße: 44,5 x 3 cm SP Spezialsiebdruck. Fläche: 180 x 20 Preis/Stk.:mmab 200 Stück -,40 Werkzeugkosten:
ausAußentascheNetzgewebe 3 SHOPPER Außenfach/SeitentascheNON-WOVEN Geräumiger Shopper aus dem extraleichten Vliesstoff Non Woven. Besonders praktisch: zwei aufgesetzte Außentaschen, eine davon aus Netz. Maße: 38 x 33 x 11 cm SP Spezialsiebdruck. Fläche: 250 x 120 mm Preis/Stk.: ab 50 Stück -,50 Werkzeugkosten: Siehe Serviceseiten. 179 192 blau -,79 2 FILZ UMHÄNGETASCHE Diese Umhängetasche aus hochwertigem Kunstfilz ist ideal für den Einsatz auf Messen und Veranstaltungen geeignet. Das zeitlose Design gepaart mit der hohen Langlebigkeit sorgt für optimale Werbewirkung! Maße: 35 x 30 x 5 cm SP Spezialsiebdruck. Fläche: 200 x 100 mm Preis/Stk.: ab 25 Stück -,95 Werkzeugkosten: Siehe Serviceseiten. 135 865 rot 1,99 1 FILZ HAFTNOTIZZETTEL-BUCH Ein raffi nierter Umschlag aus Kunstfi lz macht dieses Haftnotizzettel-Buch mit Haftnotizen in zwei Größen und vier Farben zu einem besonderen Hingucker. Maße: 8,5 x 8 x 1,5 cm SP Spezialsiebdruck. Fläche: 50 x 25 Preis/Stk.:mmab 80 Stück -,45 Werkzeugkosten: Siehe Serviceseiten. 179 289 blau -,89 179 297 orange -,89 179 301 grün -,89 DRUCK 6 „PARTYFLASCHENÖFFNERTIME“ So wird Ihre Werbebotschaft zum Mittelpunkt der nächsten Party: Flaschenöffner aus Kunststoff und Metall mit großzügiger Fläche zum Bedrucken. Ein Magnet auf der Rückseite sorgt dafür, dass der Flaschenöffner griffbereit am Kühlschrank befestigt werden kann. Maße: 3,3 x 10 x 0,3 cm W Werbedruck. Fläche: 45 x 20 mm Preis/Stk.: ab 200 Stück -,20 Werkzeugkosten: Siehe Serviceseiten. D Digitaldruck 4c. Fläche: 60 x 30 mm Preis/Stk.: ab 200 Stück -,45 Datenhandling: einmalig 29,187 562 weiß -,29 187 587 blau -,29 187 595 rot -,29



































































































































































DRUCK4C Lieferung nur für den gewerblichen Bedarf. Alle Preise zzgl. MwSt.330 | SALES 1 „BARCELONA“KLICKKUGELSCHREIBER Transparenter farbiger Kunststoff sorgt bei diesen Kugelschreibern mit blauschreibender Mine für eine besonders schöne Optik. Die gerillte gummierte Griffzone gibt sicheren Halt. Das EinKlick-System am Drücker wird durch leichtes Tippen am Klipp wieder gelöst. W Werbedruck. Fläche: 35 x 5 mm Preis/Stk.: ab 500 Stück -,12 Werkzeugkosten: Siehe Serviceseiten. 187 208 rot -,09 187 224 grün -,09 187 232 orange -,09 187 249 grau -,09 4 SCHREIBER „MODERN“ Sieht gut aus und liegt gut in der Hand. Dieser Kugelschreiber mit Druckmechanismus bekommt durch seine zweifarbige Hülle sein unverwechselbar fröhliches Aussehen. Schwarzschreibende Qualitätsmine. Länge 14,3 cm W Werbedruck. Fläche: 40 x 7 mm Preis/Stk.: ab 250 Stück -,14 Werkzeugkosten siehe Serviceseiten 122 194 blau -,17 122 217 orange -,17 3 SCHREIBER „PEARL“ Seine geschwungene Form und die markante Kugel am Drücker geben diesem blauschreibendem Kugelschreiber aus Kunststoff seine individuelle Form und sorgen dafür, dass Ihr Firmenname aus der Masseheraussticht. W Werbedruck. Fläche: 30 x 6 mm Preis/Stk.: ab 400 Stück -,14 Werkzeugkosten: siehe Serviceseiten. 144 657 blau -,15 144 665 rot -,15 144 690 grün -,15 2 „CARACAS“METALL-KUGELSCHREIBER Matt leuchtende Farben und Chromelemente charakterisieren die Kugelschreiber der Serie „Caracas“. Blauschreibende Großraummine . W Werbedruck. Fläche: auf Schaft, 45 x 11 mm Preis/Stk.: ab 150 Stück -,25 Werkzeugkosten: Siehe Serviceseiten. 116 680 blau -,49 116 702 silber -,49 116 719 grün -,49 0 17 JETZTNUR 009 % 0 30 JETZTNUR 017025 JETZTNUR 015085 JETZTNUR 049




















































197 896
pentaille.
er eine
Blauschreibend inkl. Ersatzmine. W Werbedruck. Fläche: 40 x 7 mm Preis/Stk.: ab 50 Stück
Der neue
Siehe Serviceseiten. 187 312 rot -,95 187 329 blau -,95 0 85 JETZTNUR 039199 JETZTNUR 095
197 723
– zeitgemäß interpretiert. Maße: L 14 cm W
mal gehalten. Echte
0 36 JETZTNUR 009059 JETZTNUR 012 5 CARAN
197
197
-,50 Werkzeugkosten: Siehe Serviceseiten. 191 166 rot 1,95 4 1JETZT80NUR95 331SALES | 1 „SILVERADO“METALL-KUGELSCHREIBER Druck-Kugelschreiber mit Metallschaft und -Klipp. Markante Griffzone mit 6 schwarzen Gummiringen. Blauschreibende Garantie-Großraummine. W Werbedruck. Fläche: auf Schaft, 50 x 12 Preis/Stk.:mmab 200 Stück -,12 Werkzeugkosten: Siehe Serviceseiten. 104 137 schwarz -,39 104 188 rot -,39 104 129 silber -,39 2 SCHREIBGERÄT DELUXE „NOTE & LITE“ Der Kugelschreiber Deluxe aus Metall mit abnehmbarer Kunststoffkappe vereint gleich drei praktische Funktionen in einem: Seine gummierte Spitze dient als Touchpen, darüber
Fläche: 35
3 mm Preis/Stk.: ab
197
Siehe Serviceseiten. L Lasergravur. Fläche: auf Oberseite 40 x 8 mm Preis/Stk.: ab 50 Stück -,65
LED-Lampe 3 SCHREIBER „MALMÖ“ Dieser Kugelschreiber beeindruckt durch seine schlichte Eleganz. Das Gehäuse ist aus Kunststoff hergestellt, die Spitze, der Drücker und der Klipp sind in Metall verarbeitet. Die Griffmanschette lässt durch ihre Öffnungen das farbige Kunststoff des Schaftes durchblicken. Blauschreibende X 20 Mine S Siebdruck. Fläche: 40 x 12 mm seitlich vom Klipp Preis/Stk.: ab 400 Stück -,10 Werkzeugkosten: Siehe Serviceseiten. 197 966 rot -,09 197 974 orange -,09 4 GEL-SCHREIBER „CURACAO“ Dieser Kugelschreiber ist ein echter Hingucker. Durch seine gewellte Griffmanschette aus Silikon, des transparenten Drückers und der transparenten Spitze fällt er direkt ins Auge. Auch der erst gerade und dann geschwungen verlaufende Klipp machen was her. Das Gehäuse ist aus Kunststoff hergestellt. Der Kuli hat eine schwarzschreibende X-22 Gel-Mine. S Siebdruck. Fläche: 50 x10 mm seitlich vom Klipp Preis/Stk.: ab 200 Stück -,13 Werkzeugkosten: Siehe Serviceseiten. blau -,12 907 rot -,12 915 grün -,12 orange -,12 931 schwarz -,12 KUGELSCHREIBERD’ACHE „FROSTY“ Kugelschreiber mit der WesDie Mitte des sechseckigen Schafts aus Kunstharz ist auffallend schSchweizer Handwerkskunst Werbedruck. x 30 Stück hinaus enthält Taschenlampe. -,60 Werkzeugkosten: Werkzeugkosten:























2 SCHREIBER „RIGA“ Ein echter Hingucker: Bei diesem Kunststoffkugelschreiber mit weißer Softtouch-Oberfläche wiederholt sich die Farbe des Clips im auffälligen Muster des Griffbereichs. Mit blauschreibender X-20 Mine. W Werbedruck. Fläche: 45 x 7 mm seitlich vom Klipp Preis/Stk.: ab 400 Stück -,10 Werkzeugkosten: Siehe Serviceseiten. 197 845 hellblau -,09 197 853 orange -,09 197 861 gelb -,09 197 870 grün -,09 1 SENATOR KUGELSCHREIBER „LIBERTY POLISHED“ Die gradlinige Formensprache macht den in Deutschland Blauschreibend.botschaftzeitlosenKunststoffkugelschreiberhergestelltenzueinemBegleiter,derIhreWerbe-glänzendzurGeltungbringt. S Siebdruck. Fläche: in Verlängerung vom Klipp 50 x 20 mm W Werbedruck. Fläche: auf den Schaft 40 x 7 mm auf den Klipp 40 x 5 Preis/Stk.: ab 300 Stück -,10 Werkzeugkosten: Siehe Serviceseiten. 190 913 blau -,19 190 930 grün -,19 3 SENATOR CLEARSCHREIBERDREHKUGEL-„HEADLINERBASIC“ Eleganter Drehkugelschreiber mit weiß polierter opaker Gehäuseoberfläche. Im Mix mit einer glänzenden farbigtransparenten Gehäuseoberfläche sowie einem polierten opaken Klipp. Blauschreibende senator ® magic flow G2 Mine (1,0 mm). Made in Germany. S Siebdruck. Fläche: in Verlängung vom Klipp 40 x 15 mm Preis/Stk.: ab 150 Stück -,20 D Digitaldruck 4c. Fläche: auf Klipp 40 x 6 mm Preis/Stk.: ab 150 Stück -,40 Datenhandling: einmalig 29,198 143 rot -,49 198 151 grün -,49 198 178 schwarz -,49 0 32 JETZTNUR 009044 JETZTNUR GERMANYMADE019IN067 JETZTNUR 049 Lieferung nur für den gewerblichen Bedarf. Alle Preise zzgl. MwSt.332 | SALES 4 „SARAGOSSA“METALL-KUGELSCHREIBER Einfach glänzend in Farbe, Form & Funktion: eleganter Metall-DruckKugelschreiber in 3 glänzenden Farben und Mattsilber mit Klipp und Spitze aus glänzendem Metall sowie 30 gummierten Punkten für den besseren Grip am Griff. Blauschreibende Qualitätsmine. W Werbedruck. Fläche: auf Schaft, 45 x 7 Preis/Stk.:mm ab 200 Stück -,20 Werkzeugkosten: Siehe Serviceseiten. 115 092 blau -,45 115 105 rot -,45 115 113 silber -,45 115 121 schwarz -,45 0 85 JETZTNUR 045












































Dieses Plasma-Feuerzeug im Metallic-Look überzeugt durch futuristisches Design und innovative Lichtbogen-Technologie, die ganz ohne Gas und Benzin auskommt. Lieferung inklusive USB-Kabel für unkompliziertes Aufladen. Maße: 4 x 7 x 1,5 cm W Werbedruck. Fläche: 18 x 25 mm Preis/Stk.: ab 20 Stück Werkzeugkosten: Siehe Serviceseiten.
1 SMARTPHONE
700ml Diese Trinkflasche ist einfach unverzichtbar auf Reisen oder beim Sport: Sie ist leicht und bruchfest. Praktisch ist auch die Rundumtrinkkante für maximalen Trinkkomfort. Durch die große Öffnung ist die Flasche schnell und unkompliziert zu befüllen. Aus umweltfreundlichem, recycelbarem Kunststoff besonders leicht, langlebig
RINGSTÄNDER Mit diesem Ringständer liegt das Smartphone besonders gut und sicher in den Händen und kann auch auf dem Schreibtisch in die perfekte Position gebracht werden. Inklusive Chip für den Einkaufswagen. Maße: Ø 3,3 x 0,7 cm W Werbedruck. Fläche: 18 x 8 mm Preis/Stk.: ab 200 Stück -,20 Werkzeugkosten: Siehe Serviceseiten. 192 179 grün -,45 192 146 weiß -,45 0 85 JETZTNUR 045 mit Clipgegen Verrutschen 4 TURNBEUTEL MIT CLIP UND ZUGBAND Der klassische Turnbeutel feiert sein Comeback und dient längst nicht mehr nur dem Transport von Sportschuhen & Co. Besonders vielseitig ist dieses Modell aus widerstandsfähigem Polyester, extra dicker Zugbandkordel und einem praktischen Clip, der verhindert, dass die Träger von den Schultern rutschen. Maße: 44,5 x 34 x 0,3 cm SP Spezialsiebdruck. Fläche: 220 x 150 mm Preis/Stk.: ab 30 Stück -,45 Werkzeugkosten: Siehe Serviceseiten. 175 786 rot 1,99 3 1JETZT90NUR99 333SALES | 7 25 JETZTNUR 495 15 95 JETZTNUR 885 1 95 JETZTNUR 099%
MADE GERMANYIN
und spülmaschinengeeignet sowie selbstverständlich frei von BPA und Melamin. Maße: Ø 9 x 22 cm W Werbedruck. Fläche: 35 x 50 mm seitlich Preis/Stk.: ab 8 Stück 4,25 Werkzeugkosten: Siehe Serviceseiten. 207 278 organic-grey 8,85 207 317 organic-green 8,85 2 LED-TASCHENLAMPE „LITTLE LIGHTENING“ Dieser Schlüsselanhänger in 4 Farben mit LEDLeuchte lässt Sie nirgends im Dunkeln stehen. Inkl. 2 Knopfzellen-Batterien. Maße: inkl. Schlüsselring Ø 2 x 9 cm W Werbedruck Fläche: Lampe: 25 x 10 mm Preis/Stk.: ab 60 Stück -,65 Werkzeugkosten: Siehe Serviceseiten. 115 603 rot -,99 MitEinkaufschip
1,80
5 KOZIOL TRINKFLASCHE XXL „SAFE TO GO“
192 058 blau 4,95 192 066 silber 4,95
3
AufladenperUSB,. USB FEUERZEUG
























































































ÜBERALL EINFACHER SCHUTZ! 1 BLOCKERDATENÜBERTRAGUNGS-DATASHIELD Mit diesem Adapter können Smartphones, Tablets & Co. bedenkenlos auch an öffentlichen Ladestationen geladen werden, ohne dass Computerviren übertragen werden oder die Gefahr von Datendiebstahl besteht. Der Adapter sorgt dafür, dass nur der Ladestrom durchgelassen wird, nicht aber Daten. Für USB Typ A zu USB Typ A geeignet, aus Kunststoff und Metall. Maße: 4,1 x 2,6 cm W Werbedruck. Fläche: 20 x 15 mm Preis/Stk.: ab 100 Stück -,30 Werkzeugkosten: Siehe Serviceseiten. D Digitaldruck 4c. Fläche: 20 x 20 mm Preis/Stk.: ab 100 Stück -,75 Datenhandling: einmalig 29,200 223 weiß -,59 200 231 schwarz -,59 4C super flachDRUCK4C DRUCK 2 MASSBAND 5m „HOME IMPROVEMENT“ Ein tolles Werbegeschenk für Freizeit- und Profihandwerker gleichermaßen. Das hochwertige Maßband aus Stahl in einer Kunststoffhülle überzeugt mit Einrollfunktion, Automatik mit Feststeller, Gürtelclip auf der Rückseite sowie einer Trageschlaufe. Maße: 6,8 x 6,4 x 2,4 cm W Werbedruck. Fläche: 40 x 30 mm Preis/Stk.: ab 70 Stück -,40 Werkzeugkosten: Siehe Serviceseiten. 181 687 grau 1,39 2 29 JETZTNUR 139 6 45 JETZTNUR 395 mithervorragenderStickerei 4 25 JETZTNUR 295 4 ALUMINIUM SOFTTOUCH TRINKFLASCHE Eine tolle Trinkflasche mit Zieh-/Druckverschluß für den Sport, die dank SoftTouch-Oberfläche auch bei Nässe nicht aus der Hand rutscht. Nur für Handspülung geeignet. Maße: Ø 7 x 20,5 cm Füllmenge: 600 ml W Werbedruck. Fläche: 30 x 45 mm Preis/Stk: ab 30 Stück 1,20 Werkzeugkosten: Siehe Serviceseiten. 190 446 schwarz 1,99 190 454 blau 1,99 3 USB-STICK SCHECKKARTE Praktischer kann USB kaum sein: flach und im Scheckkarten-Standard-Format. Passt in jede Brieftasche. Hinweis: Die GEMA-Gebühren für USB-Sticks sind in unseren Verkaufspreisen enthalten und werden abgeführt. D Digitaldruck 4c. Fläche: 80 x 50 Preis/Stk.:mmab 10 Stück 2,95 Datenhandling: einmalig 29,138 503 8 GB 3,95 5 STIRNBAND MIT LED Ob zum Joggen oder für den Abendspaziergang – dank integriertem LED-Licht sorgt das Stirnband dafür, dass Sie auch in der Dämmerung und bei Dunkelheit bestens sehen und gesehen werden. Betrieb über 1x CR2032 Batterie, im Lieferumfang enthalten. Maße: Einheitsgröße M ST Stickerei. Fläche: 90 x 30 mm Preis/Stk.: ab 20 Stück 3,50 Werkzeugkosten: Siehe Serviceseiten. 187 415 grau 2,95 187 423 schwarz 2,95 Lieferung nur für den gewerblichen Bedarf. Alle Preise zzgl. MwSt.334 | SALES 1 15 JETZTNUR 059 4 75 JETZTNUR 199































































ZUCKERROHR
BAUMWOLLE
RECYCLING Müll wird als Rohstoff wiederverwendet. Mehr Weiterverwendung und Recycling sind der Schlüssel zu mehr Umweltschutz durch Kreislaufwirtschaft. Produkte müssen ressourceneffizienter und langlebiger werden. Je öfter unser Müll als Rohstoff im Kreislauf geführt wird, desto besser.
Eine nachhaltige und umweltfreundliche Alternative für die Plastik- und Papierproduktion, bei der viel weniger Energie aufgewendet wird. Produkte aus Zuckerrohr sind nach Gebrauch biologisch abbaubar, zersetzen sich schnell und werden zu Erde.
VEGAN VEGAN „Vegan“ beschreibt einen Ernährungs- bzw. Lebensstil ganz ohne tierische Erzeugnisse. Veganer verzichten auf Fleisch, Milch, Eier, Butter, Honig sowie auf deren Derivate. Für viele Veganer geht die Einstellung sprichwörtlich über den Tellerrand hinaus – sie bevorzugen ein Leben ohne Wolle, Seide und Leder.
Das bioloisch abbaubare Material zersetzt sich durch biologische Aktivität, beispielsweise Mikroorganismen oder Enzyme. Nach der Zersetzung bleiben Wasser, Biomasse und Kohlenstoffdioxid zurück. Der Zeitraum ist unerheblich.
UMWELTFREUNDLICH
Ganz nach dem Motto „Aus Alt mach Neu“ entstehen durch Upcycling aus scheinbar nutzlosen Abfallprodukten ganz neue, oftmals überraschende und wertvolle Dinge. Diese Nachnutzung von Rohstoffen schont unsere natürlichen Ressourcen erheblich.
NACHHALTIGKEIT
Positiv für das eigene Unternehmen und Stärkung des Wirtschaftsstandortes Europa. Durch Bevorzugung regionaler Hersteller werden nicht nur die Transportwege kürzer und der CO2-Ausstoß reduziert, sondern auch die Wertschöpfung im eigenen Land vergrößert.
FREE BPA-FREIER KUNSTSTOFF BPA-freies Plastik wird häufi g aus dem Tritan Copolyester oder aus Polypropylen hergestellt. Beide Materialien sind frei von hormonell wirksamen Substanzen wie BPA und frei von Weichmachern wie Phtalaten.
Soziales Engagement von Unternehmen lohnt sich! Es kommt nicht nur den Betroffenen zugute, sondern stärkt auch das Image und Profil des Unternehmens. Darüber hinaus wird bei den Beschäftigten ein Bewusstsein für soziale Bedarfslagen geschaffen.
Blumen- und bienenfreundliche Produkte sind wichtig, um das Gleichgewicht unserer Umwelt wieder herzustellen. Ein kleiner Beitrag, den jeder leisten kann.
KORK Kork ist sehr nachhaltig, da er vom Baum stammt, dieser aber nicht gefällt werden muss. Nur die nachwachsende Rinde der Korkeiche wird geerntet. Kork ist daher ein effizienter, erneuerbarer Rohstoff, der auch keinen Abfall erzeugt. Dies liegt daran, dass Kork sowohl recycelbar als auch biologisch abbaubar ist.
WEIZENSTROH Tatsächlich handelt es sich bei dem genutzten Rohstoff um ein Abfallprodukt aus der Landwirtschaft, welcher anstelle von Kunststoff eingesetzt werden kann. Produkte aus Weizenstroh sind frei von den üblichen Weichmachern und Konservierungsstoffen.
UP UPCYCLING
GLAS Glas ist zu 100 Prozent recycelbar und ohne Qualitätsverlust unendlich oft wiederverwendbar. Das macht Glas zu einem nachhaltigen Werkstoff und Altglas zu einem wertvollen Rohstoff.
Baumwolle ist per se ein nachwachsender Rohstoff und – essenziell wichtig - biologisch abbaubar. Die gesamte Baumwollpflanze wird für die Ernte verwendet. Der wirtschaftliche Aspekt gehört ebenfalls zur Nachhaltigkeit: Im Baumwollanbau verdienen grob geschätzt rund 200 Millionen Menschen ihren Lebensunterhalt.
HTHAL AT FREE HTHA L AT FRE PHTHALATFREI Phthalate werden als Weichmacher für Kunststoffe eingesetzt. Allerdings können sich diese chemischen Verbindungen schädlich auf die Gesundheit auswirken. Werden bei einem Produkt phthalatfreie Weichmacher verwendet, sind diese gesundheitlich unbedenklich und eignen sich sogar für Kinderspielzeug.
Wenn es um wertige Produkte mit hoher Langlebigkeit geht, können bio-basierte Kunststoffe eine tolle Alternative sein. Diese werden auf Basis von nachwachsenden Rohstoffen wie Mais, Zuckerrohr, Zuckerrüben, Raps oder Palmöl erzeugt und unterscheiden sich in ihren Eigenschaften nicht von konventionellen Kunststoffen.
USE WIEDERVERWENDBAR
SOZIALES ENGAGEMENT
RECYCELTES PAPIER Recyclingpapier wird durch die Wiederverwertung von Altpapier, Pappe sowie Karton gewonnen. Es muss kein Holz geschlagen werden. Für die Herstellung wird weniger als die Hälfte an Energie und bis zu 70 Prozent weniger Wasser als für Frischfaserpapier benötigt.
BIOLOGISCH ABBAUBAR
Was, wenn Verpackungen CO2 - neutral wären und keine Auswirkungen auf das Klima hätten? Diese Verpackungen bestehen schon heute größtenteils aus nachwachsenden oder recycelten Rohstoffen und erzeugen in der gesamten Herstellungs- und Transportkette weniger CO2
JUTE Jute zerreißt nicht und ist nahezu „unkaputtbar“. Außerdem ist die reine Jute zu 100% biologisch abbaubar, was für ein wirklich gutes Gefühl sorgt. Ein Jutebeutel kann weit über hundert Tragetaschen aus Plastik ersetzen und ist heute moderner und angesagter denn je.
HOLZ Holz aus nachhaltiger Waldwirtschaft ist äußerst umweltfreundlich, da Bäume CO2 absorbieren und Sauerstoff produzieren. Auch nach einem langen Lebenszyklus wirken sich Holzprodukte günstig auf die Umwelt aus: Holz lässt sich problemlos wiederverwerten oder umweltfreundlich entsorgen.
BAMBUS Bambus boomt und ist als Ersatz für Plastik absolut sinnvoll. Bambus ist ein schnell nachwachsender Rohstoff, der sehr widerstandsfähig gegenüber Umwelteinflüssen ist. Ein weiterer Pluspunkt: Bambuspflanzen binden bis zu viermal mehr CO2 als andere Baumarten.
HERGESTELLT MIT ÖKOSTROM
LEDER Leder ist ein hochwertiger Naturstoff. Es ist überaus strapazierfähig und alterungs- sowie temperaturbeständig. Da es sich um ein Naturprodukt handelt, dass sich mit der Zeit verändert, ist eine regelmäßige Pfl ege sehr wichtig. So bleiben die tollen Eigenschaften für eine lange Freude am Produkt erhalten.
BIENEN & BLUMEN
ORGANIC ORGANIC PLASTIC
335SERVICE | ICONS
Unter echtem Ökostrom versteht man Strom von einem unabhängigen Anbieter, der ausschließlich umweltschonend erzeugten Strom verkauft und gleichzeitig in den Aufbau von Wind- oder Wasserkraftanlagen investiert.
TEP RPET / PET Recycelter Kunststoff und RPET sparen den Einsatz fossiler Brennstoffe in der Produktion. Außerdem wird bei der Herstellung von RPET weniger CO2 ausgestoßen und weniger Wasser als bei Kunststoff verwendet. Wie wäre es wenn all die Millionen von PET-Flaschen ab jetzt ein zweites Leben bekämen, anstatt den Plastikberg immer größer werden zu lassen?
big
Ihre Bestellung können Sie uns auch gerne per E-Mail an werbedruck@oppermann.de oder auf Datenträger zuschicken (bitte nur Datenkopien, da wir keine Datenträger zurück senden). Wir arbeiten mit den Programmen Adobe Illustrator CC 2022, CorelDraw SE 2018 und Adobe Photoshop CC 2022 sowie Adobe InDesign CC 2022 (Bilder und EPS bei Import bitte einbetten). Bildformate wie TIFF und JPEG sollten eine mind. Auflösung von 300 dpi bei 1:1 haben.
Für Firmenlogo, Sonderschriften usw. benötigen wir reprofähige z. B. Briefkopf oder (keine pien oder Stempelabdrücke).
S
Bitte fügen Sie bei schriftlichen Bestellungen einen Papierausdruck bei. Grafikformate wie EPS, PDF und Al, bei denen die Schriften nicht mitgeliefert werden können, wandeln Sie bitte in Kurven bzw. Pfade um oder legen Sie den Schrift-Font (Schriftart) bei. Bei Folgebestellungen haben wir Ihren Werbetext bei uns im System archiviert. Sie können alle Farben und gängigen Schriftarten frei wählen. Wenn Sie uns keine Angaben zur Größe des Druckes, Druckfarbe und Druckposition machen, realisieren wir diese nach unseren gestalterischen IhreErfahrungswerten.OPPERMANN-Spezialisten garantieren Ihnen eine professionelle Beratung und wunschgemäße Umsetzung Ihrer Werbeideen.
Die aus diese
Film, Reinzeichnung,
Visitenkarte
FARBEN
HKS 7 HKSGOLD92HKS 13 HKS 78 HKS 64HKSSILBER39HKS4 HKS 33
unten stehenden Standardschriftarten aus,
Kostenlose Hotline 0800 - 567 21 21 RUND UM DEN DRUCK Individuelle, hochwertige Werbung. Kleine Stückzahlen möglich. D DIGITALDRUCK Mehr farbiges Druckverfah-
Lieferung nur für den gewerblichen Bedarf. Alle Preise zzgl. MwSt.336 | SERVICE GOLDFARBBEISPIELESILBER
Vorlagen,
Telefaxe, Fotoko-
angegebenen Farbbeispiele sind nicht druckverbindlich. Weitere Farben finden Sie in unserem Onlineshop. STANDARDSCHRIFTEN Wählen Sie
BITTE BEACHTEN SIE FOLGENDE PUNKTE:
DRUCKVORLAGENUNDTRANSFER UND SCHRIFTEN ren auchAuch mehrfarmöglich. SIEBDRUCK Spezielles Runddruckverfahren für Schreibgeräte. Dauerhafte Werbung z. B. auf undMetallschreibgeräteMesserklingen. Ermöglicht fast unbegrenzte P PRÄGUNG Verleiht z.B. Lederartikeln eine edle Erscheinung durch fühlbares Motiv.
für Textilien T TAMPONDRUCK Universelles Bedrucken fast aller Artikel.
AUS EINER HAND Eine der Stärken von OPPERMANN ist die Vielfalt der im eigenen Haus vorhandenen Veredelungstechniken. So können alle möglichen Materialien mit Logos, Einzelnamen oder auch Bildern versehen werden. Und das in kürzester Zeit und in optimaler Qualität.
TF TRANSFERDRUCK Besonders für Textil- und Outdoorartikel geeignet.
sind im Grundpreis mit enthalten. Weitere Sonderschriften erhalten Sie gerne auf Anfrage. SCHRIFTENAUSWAHLABCDEFGHIJKL XWVUTSRQPONM
SUBLIMATIONSDRUCK Farbige Werbebotschaften in brillanter Qualität.
ST STICKEREI Hochwertige Werbeanbringung für Textilien. SP TEXTILDRUCK Großflächige Werbung für Taschen, Schirme und Bekleidung.

































Bei telefonisch übermittelten Texten für evtl. Werbeaufdrucke etc. kann keine Gewähr übernommen werden. Das Risiko trägt der Auftraggeber. Wir empfehlen, die Texte grundsätzlich schriftlich zu übermitteln. Mit der Auftragserteilung für Werbeaufdrucke stellt uns der Kunde von etwaigen Ansprüchen Dritter wegen Verletzung von Kennzeichnungsrechten oder anderen Rechten Dritter frei, die infolge der Ausführung des Auftrages etwa gegen uns geltend gemacht werden, und gestattet uns die Benutzung etwaiger eigener Schutzrechte, soweit sie Gegenstand des auftragsgemäßen Werbeaufdrucks sind. Die Ablehnung oder der Rücktritt von Aufträgen, die eine Schutzrechtsverletzung mit sich bringen, bleibt vorbehalten. Bei Bestellung mit Werbeanbringung behalten wir uns aus technischen Gründen eine 5%-ige Mehr- oder Minderlieferung vor, bei Tassen bis 15%.
10. EIGENTUMSVORBEHALT Die gelieferte Ware bleibt bis zur restlosen Bezahlung unser Eigentum. Wird die Ware vorher verkauft, so gilt die dabei entstandene Forderung als an uns abgetreten. Gehen aus der Forderung Beträge ein, so sind diese an uns abzuführen.
4. DRUCKAUFTRÄGE
gen mit datenschutzrechtlichem Charakter ist die HACH GmbH & Co. KG, Gutenbergstr. 4-6, 64319 Pfungstadt, Tel.: +49 (0)6157 / 801-0, EMail: Internet-Adresse:service@hach.de,www.hach.de 11.2 Datenschutzinformation Wir sind daran interessiert, die Kundenbeziehung mit Ihnen zu pflegen und Ihnen Informationen und Angebote, wie diesen Katalog zukommen zu lassen. Deshalb verarbeiten wir auf Grundlage von Artikel 6 (1) (f) der Europäischen Datenschutz-Grundverordnung – auch mit Hilfe von sorgfältig ausgewählten Dienstleistern – Ihre Daten, um Ihnen Informationen und Angebote von uns und anderen Unternehmen zuzusenden. 11.3 Widerspruchsrecht Wenn Sie dies nicht wünschen, können Sie jederzeit bei uns der Verwendung Ihrer Daten für Werbezwecke widersprechen, auch per E-Mail senden an service@oppermann.de. 11.4 Anfragen an unseren Datenschutzbeauftragten Unseren Datenschutzbeauftragten erreichen Sie ebenfalls unter unserer Anschrift oder unter datenschutz@oppermann.de. 11.5. Weitere Informationen zur Datenverarbeitung und Ihrer Rechte Weitere Informationen zum Datenschutz erhalten Sie unter https://www.oppermann.de/datenschutz/ Unser diesbezüglicher Datenschutzhinweis zur Website/Online-Shop gilt sinngemäß.
12.ERFÜLLUNGSORTUNDGERICHTSSTAND Erfüllungsort für Lieferung und Zahlungen ist Pfungstadt. Gerichtsstand für beide Teile ist das Amtsgericht Darmstadt.
ALLGEMEINE GESCHÄFTSBEDINGUNGEN
Im Falle einer mangelhaften Lieferung kann der Käufer Minderung oder Wandelung verlangen. Offensichtliche Mängel sind unverzüglich, spätestens innerhalb einer Ausschlussfrist von 30 Tagen nach Empfang der Ware zu beanstanden. Wir leisten keine Gewähr für Schäden, die auf Störungen, unsachgemäße Bedienung oder natürlichen Verschleiß zurückzuführen sind. Wegen Verzug, Unmöglichkeit der Leistung, Verletzung von vertraglichen und gesetzlichen Neben- und Schutzpflichten und Verschulden bei Vertragsschluss sind Schadensersatzansprüche ausgeschlossen, es sei denn, der Besteller weist nach, dass der Schaden durch grob fahrlässiges oder vorsätzliches Handeln unsererseits verursacht worden ist, dass eine zugesicherte Eigenschaft fehlte, oder dass eine wesentliche Vertragspflicht schuldhaft verletzt wurde. Im letzteren Falle haften wir nur für denjenigen Schaden, der für uns bei Berücksichtigung der Umstände des Falles vorhersehbar war. In jeden Katalog können sich Druckfehler einschleichen. Wir bitten, dies zu entschuldigen und können hierfür leider keine Haftung übernehmen.
24-STUNDEN-LIEFERSERVICE
1. ALLGEMEINES Alle Angebote, Bestellungen, Aufträge und Lieferungen erfolgen ausschließlich gemäß unseren allgemeinen Geschäftsbedingungen. Jegliche Abweichungen müssen von uns schriftlich bestätigt werden. Dieser Katalog richtet sich nur an Käufer, die die Ware ausschließlich in ihrer selbstständigen beruflichen, gewerblichen, behördlichen oder dienstlichen Tätigkeit verwenden. Dieses ist uns auf Verlangen nachzuweisen. Mit der Auftragserteilung bestätigt der Käufer die entsprechende Verwendung der Ware.
WERBESERVICE WIR SIND PERSÖNLICH FÜR SIE DA! Nutzen Sie die ganze Kompetenz und Erfahrung Ihres OPPERMANN-Teams. Teilen Sie unseren Fachleuten mit, was für eine Werbeaktion Sie planen. Lassen Sie sich beraten und anregen, wie Ihre Ideen optimal umgesetzt werden können. OPPERMANN bietet Ihnen eine Vielfalt von Möglichkeiten, nahezu jeden gewünschten Artikel professionell zu bedrucken.
Bei Auftragserteilung bis 14.00 Uhr liefern wir, Warenverfügbarkeit vorausgesetzt, gegen einen Aufpreis von 13,– € auf Wunsch innerhalb von 24 Stunden.
5. VERPACKUNG Die Verpackung wird zum Selbstkostenpreis berechnet.
6. LIEFERUNG Die Lieferung erfolgt grundsätzlich auf Gefahr des Empfängers, Versand und Verpackung erfolgen nach bestem Ermessen auf Rechnung des Empfängers. Für Versand und Verpackung innerhalb Deutschlands berechnen wir folgende Pauschalen: bis zu einem Auftragswert von 50,- € = 6,95 € bis zu einem Auftragswert von 100,- € = 10,95 € über einem Auftragswert von 100,- € = 12,95 € Für Expressversand innerhalb Deutschlands wird ein Zuschlag von 13,- € auf die o. g. Versandpauschalen erhoben. Für den Versand ins Ausland ermitteln wir die Kosten auf Basis des Sendungsgewichts individuell. Eine Transportversicherung wird von uns abgeschlossen und mit 0,99 € dem Empfänger der Sendung in Rechnung gestellt.
9. GEWÄHRLEISTUNG UND HAFTUNG
7. RÜCKGABERECHT
337SERVICE |
48-STUNDEN-EXPRESSDRUCK
Alle Preise zur Werbeanbringung beziehen sich, soweit nicht anders angegeben, auf eine einfarbige und einseitige Anbringung. Je Artikeltyp, Motiv, Farbe und Seite fallen Grundkosten für die Herstellung der Druckklischees und die Maschineneinrichtung an. Bei Sonderschriften, Firmenzeichen bzw. Logos entstehen außerdem Zusatzkosten. Mehrfarbendruck auf Anfrage. Druckfarbenwechsel auf Kundenwunsch berechnen wir mit Euro 12,50. Auf Wunsch erhalten Sie vor der endgültigen Fertigstellung einen kostenlosen Korrekturabzug oder ein Ausfallmuster für Euro 25,- zzgl. Warenwert. Nachträgliche Änderungen berechnen wir anteilig.
2. ANGEBOTE Unsere Angebote sind grundsätzlich freibleibend. Ein Auftrag gilt erst nach unserer schriftlichen Bestätigung als verbindlich. Den Rücktritt von einem Auftrag behalten wir uns für den Fall vor, dass beim Besteller eine wesentliche Vermögensverschlechterung eintritt oder wir nachträglich davon Kenntnis erhalten und der Besteller zur Leistung Zug um Zug oder zur Sicherheitsleistung nicht bereit ist.
WERBETIPP Bei diesem Preis-Hinweis bekommen Sie das jeweilige Produkt in angegebener Menge inklusive aller
Druckkosten für eine einseitige, einfarbige Werbeanbringung in Standardschriften. Bei Sonderschriften und Firmenlogos werden zzgl. Euro 13,- berechnet. WERBEANBRINGUNG TEL 080 0– 567 11 78* FAX 0800– 567 21 24* MAIL service@oppermann.de * Montag bis Freitag 7.30 – 17.30 Uhr Kostenfrei aus allen Netzen KOSTENFREIE FACHBERATUNG RUND UM DEN WERBEDRUCK WIR SIND PERSÖNLICH FÜR SIE DA! DRUCKART KOSTENGRUND- KOSTENZUSATZW Werbedruck 29,- 13,S Siebdruck 29,- 13,P Prägung 29,- 13,Ä Ätzung 29,- 13,O Offsetdruck 29,- 13,SP Spezialsiebdruck 45,- 13,ST Stickerei 55,D Digitaldruck 29,L Lasergravur 29,- 13,F Fototransfer 29,SU Sublimation 29,Druckfarbenwechsel 12,50 *Logo und Sonderschriften Kostenlose Hotline 0800 - 567 21 21
11. 11.1DATENSCHUTZHINWEISENameundAnschriftdesVerantwortlichen Verantwortlicher im Sinne der DatenschutzGrundverordnung, sonstiger in den Mitgliedstaaten der Europäischen Union geltenden Datenschutzgesetze und anderer Bestimmun-
Bei Auftragserteilung bis 11.00 Uhr liefern wir, Warenverfügbarkeit und technische Umsetzung vorausgesetzt, gegen eine Servicefee von 39,95 € auf Wunsch innerhalb von 48 Stunden. Tel. Hotline 0800-567 11 78
DRUCKKOSTEN
8. ZAHLUNG Die Zahlung hat spätestens 8 Tage nach Rechnungsstellung zu erfolgen.
Alle Artikel (ausgenommen sind Artikel mit einer Werbeanbringung) können innerhalb 30 Tagen nach Rechnungsdatum zurückgegeben werden. Bild- und Tonträger, Software, Hygieneartikel, Parfum und Lebensmittel nur bei ungeöffneter Originalverpackung.
3. PREISE Die Preise gelten ab Werk als Netto-Einzelpreise in Euro, zuzüglich der jeweils gesetzlichen Mehrwertsteuer. Sie sind bis zum Erscheinen des folgenden Kataloges gültig. Sollten außergewöhnliche Schwankungen bei Rohstoff- und Devisennotierungen auftreten, müssen wir uns Preiskorrekturen vorbehalten.
FLAUSCHIGE DECKE REUMWELTFREUNDLICHEMAUSCYCLETEMPET Lieferung nur für den gewerblichen Bedarf. Alle Preise zzgl. MwSt.338 | NEUHEITEN AUSFLEECEDECKERECYCELTEM PET Fleecedecke aus RPET mit Ziernaht, in einer mit Kordel verschließbaren RPET Tragetasche. Größe der Decke 120 x 150 cm. Auf Wunsch wird Ihre Werbung in unserer hauseigenen Druckerei auf die Tasche gedruckt. Die Fleecedecke ist waschbar und trocknergeeignet. Material: Polyester 600D RPET Maße: ca. 120 x 150 cm SP Spezialsiebdruck. Fläche: 150 x 150 Preis/Stk.:mmab10 Stück 3,95 Werkzeugkosten: Siehe Serviceseiten. 226 562 ab 7,95 AUSFLEECEDECKERECYCELTEM PET ab 7 95 USE STÜCKAB STÜCK-PREIS 1.DRUCKFARBE 1 Druckkosten5007,952508,951009,955010,952,502511,452,951011,953,9512,951,951,25-,90weitereFarben:sieheOnlineshop TEP
























A . . . . . . . . . . . . . . . . . 39, 161 Antigentest. . . . . . . . . . . . . . . 324-325 Anti-Stress 189, 280 Arbeitsleuchte 158-159 Armbänder 281 Ausweistasche/ -hülle . . . . . . . . . 181 B 222 Bälle . . . . . . 27, 90, 188-189, 271, 279 Bambus . . . . . . . . . 7-8, 41, 43, 45, 47, . . . . . . 50, 67, 76, 78, 80-82, 101, 152 Bauch-/ Gürteltasche 214 Baumwolltaschen 59-63, 210-212 Becher/ Tassen . . . . . .8-9, 21, 53, 69, . . . . . . . . . . . . . . . . . . . .71-77, 134-144, 146-148, 176-177, 309 Besteck . . . . . . . . . . . . . . .6, 13, 72, 81 Bienenhotel 83 Bio Kunststoff . . . . . . . .48-49, 68-71, . . . . . . . . . . . . . . . . . . . . 73-74, 103-104 Bio Snack . . . . . . . . . . . . . . . . . . . . . . 57 Bleistifte . . . . . . . . . . . . 43, 45-46, 92, . . . . . . . . . . . . . . . . . . . . . .171, 274, 279 Bluetooth-Geräte 314-317 Bluetooth Lautsprecher . . . . 45, 315 Bonbons . . . . . . . . . 57, 150, 283, 285 Brillenputztuch 328 Brotdose/ -box . . . . . . .69, 80,164-16570-71, Buchkalender . . . . . . . . . . . . 251-254, . . . . . . . . . . . . . . . . . . . . . .256-260, 264 Buntstifte . . . . . . . . . . . . . 47, 172, 276 C-E . . . . . . . . . . . 28 Caps 216-217 Clack-Bänder 100, 158 COB Lampe 157-159 Coffee to go . . . . . . . . .7, 9, 69, 72-77, . . . . . . . . 135, 140, 143-144, 146-148 Collegemappe . . . . . . . . . . . . . . . . 311 CONVAR 30 Covid-19 Rapid Antigentest 324-325 Danke. . . . . . 283-285, 287-288, 304 Dankeschön Box . . . . . . . . . 287, 304 Dartspiel 190 Dokumententaschen 202, 207 Dosenbistro 30 DREIMEISTER 287-288 Druckbleistift . . . . . . . . . . . . . . 41, 124 Eierbox 70 Einkaufstaschen . . .16-17, 59, 61-62, . . . . . . . . . . 64, 66, 203-204, 207-212 Einkaufswagenauslöser . 14, 23, 82, . . . . . . . . . . . . . . . . . . . . . . . . . . 184-185 Einkaufswagenchips 91, 184 EssbareErste-Hilfe-ArtikelEiskratzerEinzelnamenpersonalisierung308-309181.....35,178-179ESBIT12-13Löffel56 F 66, 194, 198 Fächer 190 Fahrradzubehör 11, 225 . . . . . . . . . . . . . . . .59, 62-63 Familientimer 235 Fangbecher 84 Faszienrolle 89 Federmappe . . . . . . . . . . . . . . . . . . 52 Feuerzeuge 91-92, 94-100, 126-133 FFP2-Masken 322-323 Fieberthermometer 327 Filz-Artikel . . . . . . .17, 205, 223, 300 Fitness-Produkte. . . . 68, 88-89, 214 Flaschenöffner. 8, 14, 22, 47, 53, 92, . . . . . .94, 98, 126, 165, 183, 185-186 Flaschentaschen . . . . . . 16, 203, 223 Fleecedecke/ -kissen 222 Flummis . . . . . . . . . . .24, 26, 279, 281 Food Bag . . . . . . . . . . . . . . . . . . . . . . 62 Frischhaltebox 6 Fruchtgummis . . .149, 283-284, 286 FRUIT OF THE LOOM . . . 37, 218-219 Funk-Thermo-Hydrometer 174 G-H 204-205 Gästehandtücher 213 Geduldspiele 26 Geldbeutel/ -börse . . . 308, 310-311 Gesichtsmaske /-schilder322-323,/-brillen326 Greenbox 173 Grillzubehör 47, 152, 312-313 Grußkarten . . . . . . . . . . . . . . . 306-307 Gürteltasche . . . . . . . . . . . . . . . . . 214 Haftnotizblöcke / zettel 22, 51, . . .54, 93, 96, 101, 166-168, 170-171 Hand-/Duschtücher 11, 213-215, . . . . . . . . . . . . . . . . . . . . . . . . . . . . . . 309 Handschuhe . . . . . . . . . . . . . . . . . . 326 Handwerker Magnetarmband 157 Handwerkerset 92 HARIBO . . . . . . . . . . . . . 149, 286, 289 HEIDEL . . . . . . . . . . . . . . . . . .283, 289 Heimwerker-Kalender . . . . . . 92, 255 Heizentlüfter 14 Helium 175 HERBERTZ 153 Herz-Artikel 150, 283, 285, 288 Holz-Artikel . . . . . .11, 18, 25, 39-43, . . . . . . . . . . . . . . . . . . . . 54, 84-88, 185 Holzspiele 84-87 Hoody 221 HOTGEN 324 Hunde-Artikel . . . . . . . . . .28-29, 224 Hygiene-Sortiment 322-328 I-J . . . . . . . . . . . . . . . 315, 317 Impfpasshülle 328 Induktionsladegerät 318 Insektenhotel 83 Isolierbecher/ -kannen 7, 140-145, . . . . . . . . . . . . . . . . . . . . . . . . . . 147-148 James & Nicholson 220-221 Jo-Jos . . . . . . . . . . . . .24, 54, 90, 190 Jonglierbälle 189 Jutetasche 60 K 33 Kabeltasche 34 Kaffeekocher . . . . . . . . . . . . . . . . . . 12 Kapselheber . . . 8, 14, 47, 53, 92, 94, . . . . . . . . . 98, 126, 165, 183, 185-186 Kapuzensweat 221 Kartenspiele 44, 191 Kekse . . . . . . . . . . . . . . . . . . 30-31, 149 Klemmbrett . . . . . . . . . . . . . . . . . . . 55 Knete 19427 Knusperhalme . . . . . . . . . . . . . . . . . 56 Kochset 12-13 Kochtopf 12-13 Kofferaumtasche 202 Kopfhörer 315-317 Kork . . . . . . . . .45, 52-53, 88-90, 205 KOZIOL 70-72 Kraftstoffkanister 10 Kräuter Garten Haus 83 Kreide 276 Kreisel . . . . . . . . . . . . . . . . . . . . . . . 275 Kubb-Spiel . . . . . . . . . . . . . . . . . . . . 25 Kuckuckspfeife 85 Kugelschreiber 18-19, 40-42, 44-45, 48-54, 91, 93-99, 101-124, 308, 321 Kühltaschen . . . . . . . . . . . . . 205, 208 KULERO. . . . . . . . . . . . . . . . . . . . . . . 56 Kultur-/ Kosmetiktaschen 17, 213 Kurbel-Lampe / Radio . . . . . . . 32-33 KÄRCHER 33 L 314 Lanyards 58, 125 Laser-Pointer 123 Leder-Artikel . . . . 181, 310-311, 260 LED-Lampen 97-98, 128,186-187,158-159,277 Lesezeichen 171 Lichtbogenfeuerzeuge 132 Lineal . . . . . . . . . . . . . . . . . . . . . . . . . 43 LIVINGUARD . . . . . . . . . . . . . . . . . 326 Logbuch 254 Luftballons 175 Luftfilter 327 Lunchbox . . . 69-71, 73, 81, 164-165 Lutscher . . . . . . . . . . . . . . . . . . . . . . 285 M 25 Made in Germany . . . . . . . 10, 15, 19, . . . . . . 22, 29, 31, 40, 46, 65, 68 – 73, 83-87, 105-107, 110-111, 124, . . . .146, 149, 161, 169-170, 179, 182, . . . . . . . . . . . .199, 243-245, 268, 288, . . . . . . . 294, 297, 299, 320, 323, 328 Malset 43, 172 Maniküre-Set 310 Masken 322-323, 326 Massage-Artikel . . . . . . 88, 175, 310 Maßband. . . . . . . . . . . . . . . . . . . . . 163 Maus 314 Memo Set 22 MAXXMEE 157, 310 Mehrweggeschirr 71, 81 Menübox . . . . . . . . . . . . . . . . . . . . . . 73 Messer . . . . . . . . . . 153, 160, 312-313 METMAXX . . . . . . . . . . . . . 49, 74, 77, . . . . . . . . . . . . . . . . .158, 313, 315, 321 Microfasertücher 176 Mikado-Spiel . . . . . . . . . . . . . . . . . 191 Mini-Buntstifte . . . . . . . . . . . . . . . 276 Mini-Locher 174 Mintcards 150-151 Mousepad . . . . . . . . . . . 176, 269, 321 Multifunktionswerkzeuge 153, . . . . . . . . . . . . . . . . . . . . . . . . . . 156, 160 Mützen. . . . . . . . . . . 65, 216-217, 309 N-O Nachhaltige Produkte . . 6-8, 14, 19, . . . . . . . . . . . . . . 22-23, 25, 34, 38-62, . . . . . . . . . . . . . . .64-76, 78-82, 86-89, 103-104, 220-221 Netzbeutel 61 Non Woven Taschen . . . . . . . 209, 275 Notfallset 34-35 Notstromaggregat 33 Notizblöcke/ -bücher/ -zettel 14, . . . . . . . . . . . . 54-55, 75, 167-169, 173 Outdoor-Artikel. . . . . . . . . . . 6, 12-13 P-Q 15, 294 Papiertaschen 173, 205 PARKER . . . . . . . . . . . . . . . . . . . . . . 122 Parkscheiben . . . . . . . . . 92, 100, 182 PETIZERS 29 Pfefferminzdosen 151 Pflasterbox/ -mäppchen 178-179 Piezo . . . . . . . . . . . . . . . . 126-131, 133 Plüschtiere . . . . . . . . . . . . . . . . . . . 271 Polo-Shirt 219-220 Posterkalender 266-267 Postkartenkalender 242 Powerbanks . . . . . . 51, 311, 318, 321 PRODIR . . . . . . . . . . . . . . . . . . . . . . 115 Puzzles 24, 86-87 Querkalender . . . 258-259, 261-264 Quietsche-Enten 189 R 16-17, 203 Radiergummis 26, 171 Recycling Produkte 44, 49-50, . . . . . . . . . . . 54-55, 58, 60-61, 64-65, . . . . . . . . . . . . 68-69, 73, 75, 244, 260 Reflektoren 100, 158, 180 Regenjacke 222 Regenschirme/ -schutz/ -ponchos . . . . . . . . . . . . . . . . . . . . 65-67, 192-199 Reisenapf . . . . . . . . . . . . . . . . . . . . 224 Reisespiele 191 Rennautos 278 Returnbälle 271 RITTER PEN . . . . . . . . . . 110-111, 124 RITTER SPORT . . . . . . . . . . . . . . . . 289 RPET . . . . . . . . . . . . . 11, 58, 64-65, 67 Rucksack . . .23, 35, 60, 63, 200-202, . . . . . . . . . . . . . . . . 204, 206, 208, 212 S 19, 177,102-107,308 SADEX 285 Schaumstoffflieger . . . . . . . . . . . . 278 Schlüsselanhänger . . .14, 53, 82, 95, 184-187, 223 Schlüsselband 58, 125 Schlüsseletui 181 SCHMIDT . . . . . . . . . . . . . . . . . . . . . 25 Schmutzfangmatte . . . . . . . . . . . . 199 Schneidebrett 80, 312 Schokolade . . . . . . 151, 283, 287-289 Schraubendreher Set 157 Schreibmappen . . . . . . . . . . . . . . . 167 Schreibsets . . . . . . . . . . . . . 41-42, 53, 122-123, 308 Schreibunterlage 266 Schürze 80 Segelflieger 278 Seifenblasen . . . . . . . . . . .15, 27, 277 Shopper. . . . . . . . . . . . . . 16, 204-205 Sicherheit 158, 180 SIEMENS 325 Smiley-Artikel 26-27, 180, 281, 288 Softflyer . . . . . . . . . . . . . . . . . . . . . 274 Soft-Touch 18, 120-121, 145 SOLID 116 Sonnenbrillen 82, 165 . . . . . . . . . . . . . . . . . . 316 Spaten . . . . . . . . . . . . . . . . . . . . . . . . 11 Spielwaren . . 24-27, 84-87, 271-282 Spielwarensets . . . 90, 271-273, 282 Spielzeugautos 25, 278 Sportbeutel/ -taschen . . . . 206, 208, . . . . . . . . . . . . . . . . . . . . . . . . . . 212, 275 Springseile 46-47282 Stabfeuerzeug . . . . . . . . . . . . . . . . 131 STABILA 100, 163 Stabkerzen 31 Stempel 281 Stifteköcher 48 Stiftetasche . . . . . . . . . . . . . . . . . . 275 Stockschirm 67, 192-193, 195-199 STORZ 288 Streichhölzer 133 Streifenkalender 240-242 Sturmfeuerzeuge . . . . . . . . . . . . . 132 Sturmstreichhölzer 31 Süßwaren Mix 286 Sweatshirts/ Jacken 218 SwissCard 156 T-U 124 Taschen . . . . . . .16-17, 23, 34-35, 52, 59-61, 63-64, . . . . . . . . . . . . . . . . .200-213, 223, 275 Taschenkalender 255, 265,257-259,268 Taschenlampen 97-98, 153, 159, 186-187, 277 Taschenmesser . . . . . . . . . 8, 152-157 Taschenrechner 174 Taschenschirm 66, 192-195 Taschentimer 261, 270 Tassen 8-9, 21, 53, 69, . . . . . . . . . . . . . . . . . . . .71-77, 134-144, 146-148, 176-177, 309 Tastatur 314 Terminplaner 255 Textmarker 166 Thermobecher/ -kannen . . . . . . . . 71, . . . . . . . . . . . . . . . . . . 140-145, 147-148 Timer . . . . . . . . . . .255-256, 259, 270 Tischkalender . . . 227, 237, 268-269 Touchpen . . . . 18, 101, 118-119, 321 Tranchierset . . . . . . . . . . . . . . . . . . 313 Traubenzucker . . . . . . . . . . . . 283-285 Trinkflaschen . . . . . .9, 20, 23, 75, 58, . . . . 68, 71, 74, 77, 141-143, 146, 177 Trinkhalme 56, 78-79 Trockenbrennstofftabletten 12-13 Trolley . . . . . . . . . . . . . . . . . . . . . . . 201 T-Shirts . . . . . . . . . . . . . . .37, 219-220 Universal-Schneider 160 Untersetzer . . . . . . . . . . . 53, 165, 183 USB-Produkte . . . . . .38, 40, 51, 132, . . . . . . . . . . . . . . . . . . . . . . . . . . 318-320 V 154-156, 312 Vogelhaus 83 Vorratsdosen/ -gläser . . . . . . . . . . . .6 Vorratsessen 30 VOSSEN 215, 309 W 83, 149 Wandkalender . . . . . . .227, 229-242,244-250 Wandplaner . . . . . . . . . 245, 266-267 Wärmekissen 190 Warnweste 180 Wassertank /Kanister 10, 31 Wasserspielzeug 188, 274, 277, 280 Wassertank . . . . . . . . . . . . . . . . . . . . 31 Weihnachten . . . . . . . . . . . . . 290-305 Werbesets. . . . .51, 90-101, 264, 283 Wireless Ladegerät/ Charger 43, 48-49, 318 Würfel . . . . . . . . . . . . . . . . . . . . . . . . 86 Wurfscheiben . . . . .65, 90, 188, 274 X-Z Zahnbürste 82 Zaubertafel. . . . . . . . . . . . . . . . . . . 279 Zauberwürfel 282 Zeckenkarte 224 Zettelbox . . . . . . . . .22, 54, 169, 268 Zettelhalter 181 Zollstöcke . . . . . 39, 92, 100, 161-163 INHALTSVERZEICHNIS 339INHALT |



FAX0800-5672124* AUS LIEBE ARTENSCHUTZZUM INSEKTENHOTEL AUS HOLZ Insektenhotel/haus zum Aufhängen aus Holz. Gefüllt mit verschiedenen natürlichen Materialien. Dient als Unterschlupf und Nistplatz für Bienen und andere Insekten. Leisten Sie einen wichtigen Beitrag zum Artenschutz! Maße: 15,2 x 7,7 x 15,9 cm 226 579 9,95 AUSINSEKTENHOTELHOLZ 9 95 BESTELLSCHEIN 2022 Kundennummer und Firma bei Fax bitte nochmal eintragen, bei Bestellung per Brief nicht erforderlich! Kundennummer Firma / Besteller * Gewünschte Werbeanbringung auf der Vorderseite eintragen , , , , , , , , , , , , , , B SEITE 2 (auch für Fax) STÜCK/SET ARTIKEL-NUMMER ARTIKEL-BEZEICHNUNG DRUCK EINZELPREIS GESAMTPREIS Bitte Euro Cent Euro Cent
























Cent , , , , , , , , , , , , , , , , , , , , , ,
Druckanweisung gesamte Brust Korrekturmuster 25,- Euro + Warenwert Korrekturabzug kostenfrei
Adresse Oppermann Gutenbergstr. 4-6 64319 Pfungstadt Tel 080 0– 567 21 21* FAx 080 0– 567 21 24* In T erne T www.oppermann .de M AIl service@oppermann .de Bestellungen per Telefax oder Telefon bitte nicht nochmals per Brief bestätigen! * kostenfrei aus dem Mobilfunk- und Festnetz H2 /22 BesTellscheIn 2022 r echnungs A nschr IFT Telefon Telefax E-Mail Adresse Datum Unterschrift/Firmenstempel (unbedingt erforderlic h) SEi TE n Anz Ahl BE i F Ax Lieferanschrift Falls abweichend von r echnungsanschrift nFirmaame des Empfängers Straße, hausnummer Plz Ort Gewünschte Werbeanbringung bei Satzschrift bitte hier eintra gen. Bei Verwendung von Firmenzeichen oder Sonderschriften: Druckvorlage (Briefkopf, Visitenkarte etc.) beilegen.
für w erbeauf D ruck StandangabeDruckfarbe:Schriftart: Textilien: Rücken linke Brustseite
Bei Folgebestellungen senden Sie uns bitte ein Muster oder eine Fotokopie vom letzten Auftrag zu. Wenn Sie uns keine Angaben zur Größe des Drucks, der Druckfarbe und der Druckposition machen, erfolgt der Druck in angemessener Größe und optimaler Farbe an geeigneter Stelle.
Bitte liefern Sie zu den Oppermann -Geschäftsbedingungen: sofort oder am (bitte ankreuzen) s tück/set a rtikel- n ummer a rtikel- b ezeic H nung D ruck e inzelpreis g esamtpreis Euro Cent Euro
Bitte
SO BUNT UND FREI BLUETOOTHISTSOUND 1:1Abbildung DROPS SPEAKER Klein, lebendig und einfach cool kommen die bunten Drops Speaker daher. Mit Bluetooth Version 4.2 oder Line-In, 3 Watt Leistung und kinderleichter Bedienung sind diese Kompaktspeaker ein Must-Have für Freizeit, Sport oder Büro. Mit individuellem Logo-Druck ein perfektes und gerne genutztes Werbegeschenk. 2 Drops Speaker miteinander gekoppelt können als Stereo Speaker genutzt werden. Maße: ca. 8 x 5 cm W Werbedruck Fläche: Vorderseite 30 x 15 mm Preis/Stk.: ab 12 Stück 2,95 Werkzeugkosten: Siehe Serviceseiten. 226 177 rot ab 6,95 226 185 schwarz ab 6,95 226 193 weiß ab 6,95 226 208 blau ab 6,95 226 216 grün ab 6,95 226 224 grau ab 6,95 226 232 orange ab 6,95 STÜCKAB STÜCK-PREIS 1.DRUCKFARBE 1 10,95 12 9,95 2,95 30 9,45 2,25 100 8,95 1,75 250 7,95 1,35 500 6,95 -,95 Druckkosten weitere Farben: siehe Onlineshop DROPS SPEAKER ab 6 95 IST KOSTENLOSE BESTELLHOTLINE TEL 080 0– 567 21 21 FAX 080 0– 567 21 24 INTERNET www.oppermann.de MAIL service@oppermann.de Nur für den gewerblichen Bedarf. Alle Preise zzgl. MwSt. Beim Druck dieses Produkts wurde durch den innovativen Einsatz der KraftWärme-Kopplung im Vergleich zum herkömmlichen Energieeinsatz bis zu 52% weniger CO2 emittiert. OPPERMANN Gutenbergstr. 4-6 64319 Pfungstadt




















































































































